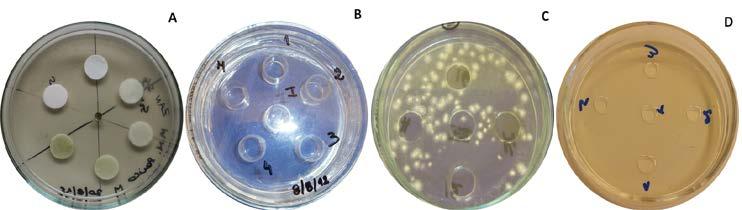
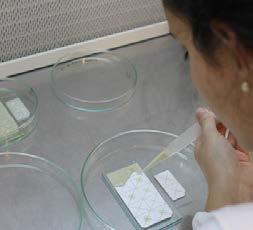
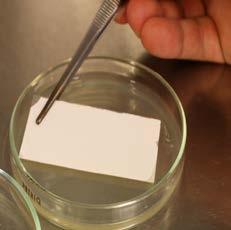
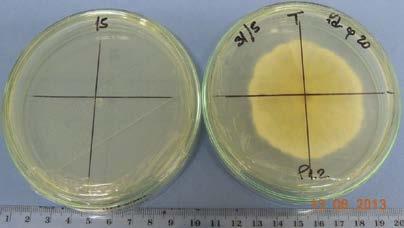
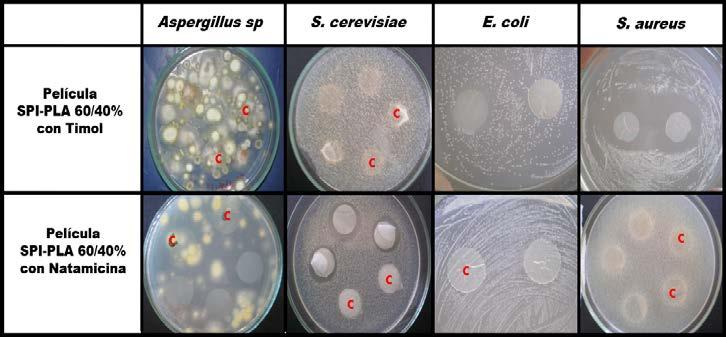

Editores
Marciel J. Stadnik
Aline C. Velho
Susana E. Zorrilla
DESENVOLVIMENTO SUSTENTÁVEL NA PRODUÇÃO
AGROALIMENTAR
DESARROLLO SOSTENIBLE EN LA PRODUCCIÓN
AGROALIMENTARIA
1º Edição Florianópolis UFSC 2019
Versão eletrônica disponível gratuitamente nos seguintes endereços:
Laboratório de Fitopatologia UFSC - http://labfitop.paginas.ufsc.br/livros/ Asociación de Universidades Grupo Montevideo (CA Agroalimentario) - http:// grupomontevideo.org/ndca/caagroalimentario/
Versão impressa pode ser solicitada ao:
LABFITOP - Laboratório de Fitopatologia
Universidade Federal de Santa Catarina-Centro de Ciências Agrárias
Rodovia Admar Gonzaga, 1346, Itacorubi
Fone: (48) 37215423 Fax: (48) 37215335 labfitop@contato.ufsc.br
Projeto Editorial e Diagramação
Marciel J. Stadnik & Aline Cristina Velho
Capa
Sarah Kirchhofer de O. Cabral
Comitê de revisores
Aline C. Velho Cláudia Luna
Diego F. Roters
Gabriela Cristiano Marciel J. Stadnik María Verónica Baroni
Marianela de Batista Patricia Lema
Rosana Rotondo
Susana E. Zorrilla
Roberta Paulert
Catalogação na fonte pela Biblioteca Universitária da Universidade Federal de Santa Catarina
D451
Desenvolvimento sustentável na produção agroalimentar [recurso eletrônico] = Desarrollo sostenible en la producción agroalimentaria / editores, Marciel J. Stadnik, Aline C. Velho, Susana E. Zorrilla – Dados eletrônicos . - 1. ed. – Florianópolis : CCA/UFSC, 2019. 318 p. : il., gráf.
Inclui bibliografia
Disponível em: <labfitop.paginas.ufsc.br/livros/> ISBN 978-65-80460-51-9 E-book (PDF) ISBN 978-65-80460-53-3 Impresso
1.Agricultura. 2. Sustentabilidade –Agricultura. 3. Desenvolvimento sustentável. I. Stadnik, Marciel J. II. Velho, Aline C. III. Zorrilla, Susana E. IV. Título: Desarrollo sostenible en la producción agroalimentaria. CDU: 63
PREFÁCIO
O desenvolvimento sustentável é considerado atualmente o paradigma dominante que guia o planejamento do desenvolvimento mundial e em particular, dos países latino-americanos. É um novo modelo de uso dos recursos naturais que não compromete a disponibilidade destes elementos para as gerações futuras, e além disso inclui componentes econômicos e sociais. Isso significa adotar um padrão de produção e consumo de modo a não afetar o futuro da humanidade, combinando harmônicamente o desenvolvimento econômico com a responsabilidade social e ambiental.
A Associação de Universidades Grupo de Montevidéu, também conhecida pelo acrônimo AUGM, é uma associação formada por universidades da Argentina, Bolívia, Brasil, Chile, Paraguai e Uruguai. Foi criada em 9 de agosto de 1991 com os objetivos de fortalecer e consolidar os recursos humanos, a pesquisa científica e tecnológica, a formação contínua e a interação de seus membros com a sociedade. A AUGM possui treze comitês acadêmicos, entre eles o Comitê Agroalimentar, que foram concebidos para abordar, com enfoque multi e interdisciplinário, grandes configurações temáticas qualificadas como estratégicas, por serem transversais e de caráter regional.
Durante as XXVI Jornadas de Jovens Pesquisadores da AUGM, realizadas em 2018 em Mendoza, Argentina, discutiu-se dentro do Comitê
PREFACIO
El desarrollo sostenible es considerado actualmente el paradigma dominante que guía la planificación del desarrollo mundial y en particular, de los países latinoamericanos. Es un nuevo modelo de uso de recursos y bienes naturales que no compromete la disponibilidad de estos elementos para las generaciones futuras y que además, incluye componentes económicos y sociales. Esto significa que se debe adoptar un patrón de producción y consumo para no afectar el futuro de la humanidad, combinando el desarrollo económico con la responsabilidad social y ambiental.
La Asociación de Universidades Grupo Montevideo, también conocida por el acrónimo AUGM, es una asociación compuesta por universidades de Argentina, Bolivia, Brasil, Chile, Paraguay y Uruguay. Fue creada el 9 de agosto de 1991 con el propósito de fortalecer y consolidar los recursos humanos, la investigación científica y tecnológica, la capacitación continua y la interacción de sus miembros con la sociedad. AUGM cuenta con trece comités académicos, incluido el Comité Agroalimentario, que fueron concebidos para abordar, con un enfoque multi e interdisciplinario, las principales configuraciones temáticas calificadas como estratégicas, ya que son transversales y de carácter regional. Durante las XXVI Jornadas de Jóvenes Investigadores de AUGM, el Comité Agroalimentario discutió la importancia y la necesidad de produ-
Agroalimentar, a importância e necessidade de se produzir uma publicação envolvendo diferentes atores em prol do desenvolvimento sustentável nos países da Associação. Na sequência, tivemos muitas sugestões de temas e de autores, por diversos membros do Comitê Agroalimentar que estavam presentes na reunião. Após uma árdua seleção, convidamos dezoito grupos de excelência para que redigissem seus capítulos em temas diversos e que se encontram reunidos nesta publicação.
O mérito e a responsabilidade de cada capítulo são devidos aos autores, aos quais expressamos os nossos agradecimentos. Queremos ainda agradecer àqueles que atuaram como revisores dos capítulos, bem como a todas as Instituições e aos colegas que acreditaram e apoiaram esta proposta.
Por fim, esperamos que esta coletânea se transforme em uma ferramenta útil de consulta àqueles que se interessam e se dedicam a estudos sobre o desenvolvimento sustentável na produção agroalimentar.
Os editores
cir una publicación incluyendo a diferentes actores para el desarrollo sostenible en los países de la Asociación. Como consecuencia, tuvimos numerosas sugerencias de temas y autores por parte de los miembros del Comité Agroalimentario que estuvieron presentes en la reunión. Después de una ardua selección, invitamos a dieciocho grupos de excelencia a escribir sus capítulos sobre los temas que se reúnen en esta publicación.
El mérito y la responsabilidad de cada capítulo son de los autores, a quienes expresamos nuestro agradecimiento. También queremos agradecer a quienes actuaron como revisores de los capítulos, así como a todas las instituciones y colegas que creyeron en esta propuesta.
Finalmente, esperamos que esta colección se transforme en una herramienta de consulta útil para todos aquellos que se interesan y se dedican a estudios sobre el desarrollo sostenible en la producción agroalimentaria. Los editores
Marciel J. Stadnik é Engenheiro Agrônomo formado pela Universidade Federal de Santa Catarina (UFSC), Mestre em Fitopatologia pela Universidade Federal de Viçosa (UFV), Doutor em Ciências Agrárias pela Universität Hohenheim (Alemanha). Realizou estágio pós-doutoral na Embrapa Meio Ambiente (Jaguariúna-SP) e foi professor visitante na University of Kentucky (EUA). Atualmente é pesquisador (PQ-1D) do CNPq e Professor Titular no curso de Agronomia e nos programas de pós-graduação em Recursos Genéticos Vegetais e em Agroecossistemas da UFSC, nos quais desenvolve estudos sobre produção sustentável de alimentos e métodos alternativos para o controle de doenças de plantas. Desde 2013, vem atuando como representante da UFSC no Comitê Agroalimentar da AUGM.
Aline C. Velho é Engenheira Agrônoma e Mestre em Produção Vegetal pela Universidade do Estado de Santa Catarina (UDESC), e Doutora em Ciências com ênfase em Recursos Genéticos Vegetais (RGV) pela Universidade Federal de Santa Catarina (UFSC). Realizou estágios pós-doutorais na Université du Littoral Côte d’Opale (França) e em RGV na UFSC. Atualmente é pesquisadora de pós doutorado (PNPD-CAPES) no Programa de Pós Graduação em Agroecossistemas (UFSC), no qual realiza estudos sobre diversidade populacional de fungos fitopatogênicos e manejo ecológico de doenças de plantas.
Susana E. Zorrilla es Ingeniera Química de la Universidad Nacional de Salta (UNSa, Argentina) y Doctora en Ingeniería Química de la Universidad Nacional del Litoral (UNL, Argentina). Ha realizado estancias de investigación en la University of California (Estados Unidos) y en KU Leuven (Bélgica) como Profesor Visitante. Actualmente, es Investigadora Principal de CONICET en el Instituto de Desarrollo Tecnológico para la Industria Química (INTEC, UNL-CONICET) y Profesora Adjunta en el Departamento de Ingeniería de Procesos de la Facultad de Ingeniería Química (FIQ, UNL), en Santa Fe (Argentina). Ha realizado contribuciones en el área de modelado y simulación de procesos de la industria de alimentos. Es Representante de UNL en el Comité Académico Agroalimentario de AUGM desde 2010 y Coordinadora del mismo desde 2018.
SOBRE OS EDITORES
INSTITUIÇÕES pARTICI pANTES
ARGENTINA
Consejo de Investigaciones Científicas y Técnicas (CONICET)
Instituto Nacional de Tecnología Agropecuaria (INTA)
Universidad Católica de Córdoba (UCC)
Universidad Nacional de Córdoba (UNC)
Universidad Nacional de La Rioja (UNLaR)
Universidad Nacional de Rosario (UNR)
Universidad Nacional de San Luis (UNSL)
Universidad Nacional del Litoral (UNL)
Universidad Nacional del Nordeste (UNNE)
Universidad Nacional del Sur (UNS)
BRASIL
Centro Nacional de Pesquisas em Agrobiologia (CNPAB-EMBRAPA)
Universidade Federal de Lavras (UFLA)
Universidade Federal de Santa Catarina (UFSC)
Universidade Federal de Santa Maria (UFSM)
Universidade Federal de São Carlos (UFSCAR)
Universidade Federal do Paraná Setor Palotina (UFPR)
CHILE
Universidad de Playa Ancha (UPLA)
pARAGUAY
Universidad Nacional de Asunción (UNA)
URUGUAY
Instituto Nacional de Investigación Agropecuaria (INIA)
Universidad de la República (UdelaR)
1-Desenvolvimento sustentável na produção agroalimentar da 3 América do Sul
Marciel J. Stadnik, Aline C. Velho, Susana E. Zorrilla
2-Conservação da biodiversidade nos agroecossistemas
Renata Evangelista de Oliveira & Luiz Fernando D. de Moraes
3-Fertilidade do solo e nutrição na produção e sanidade de plantas
Cledimar R. Lourenzi, Jucinei J. Comim, Arcângelo Loss, Paulo A. A. Ferreira, Monique Souza, Lucas Benedet, Guilherme W. Ferreira, Lucas D. Giumbelli
4-Manejo ecológico de pragas e doenças na produção agroalimentar
Aline C. Velho, Marciel J. Stadnik, Alex S. Poltronieri, Pedro Mondino
5-Cultivo de plantas medicinais: integração do conhecimento
19
35
53
73 tradicional e científico
Roberta Paulert, Patricia da Costa Zonetti, Juliano Cordeiro, Carina Kozera, Suzana Stefanello
6-Productos del nordeste argentino destinados a infusiones
89 Marcos G. Maiocchi, Elisa M. Petenatti, Luis Á. Del Vitto
7-Metodologías para el desarrollo de ecofungicidas basados
111 en aceites esenciales
Elena Perez Faggiani & Eduardo Dellacasa Beltrame
8-Sistemas agroforestales y silvopastoriles
Mónica Dorado, Mónica Arias, Marcos Sánchez
9-Estrategias para una producción sustentable en ganadería
María Verónica Aimar
131
149
ÍNDICE
10-Repensando los territorios para generación de bioenergía
Gabriela Cristiano & Marianela de Batista
11-Paisajes productivos
Ana Ruth Meehan, Alicia Elena Bobone, María Virginia Piñero, Isabel Alejandra Francia
169
181
12-Quesos artesanales ancestrales y el agregado de valor 193
Olga Myriam Vasek & Natan de Jesus Pimentel Filho
13-Economía circular: valorización de residuos orgánicos
213 provenientes del sector agroalimentario
Gabriela Cristiano
14-Utilización de residuos de la industria agroalimentaria para 235 el desarrollo de biomateriales
Agustín González & Cecilia I. Alvarez Igarzabal
15-Técnicas amigables con el medio ambiente para la 249 descontaminación de frutas finas
Franco Van de Velde, María P. Méndez-Galarraga, Andrea M. Piagentini, María E. Pirovani
16-Inocuidad alimentaria: una necesidad camino a la 267 sustentabilidad
Laura Mereles & Eleuterio Umpiérrez
17-Pérdidas en la cadena de producción y comercialización 287 de alimentos
Rosana Rotondo, Mauricio O. Mackinson, David Balaban, Rodolfo Grasso, María C. Mondino, Paula Calani, Eduardo Vita Larrieu, Gabriela Montian
18-Alternativas de mercado para o desenvolvimento da 307 agricultura familiar
Oscar José Rover & Pablo Saravia Ramos
1
DESENVOLVIMENTO SUSTENTÁVEL NA PRODUÇÃO AGROALIMENTAR DA AMÉRICA DO SUL
Marciel J. Stadnik1, Aline C. Velho1, Susana E. Zorrilla2,3
1 Universidade Federal de Santa Catarina (UFSC), Centro de Ciências Agrárias, Programa de Pósgraduação em Agroecossistemas, Rod. Admar Gonzaga, 1346, 88034-001, Florianópolis-SC, Brasil. E-mail: marciel.stadnik@ufsc.br
2 Universidad Nacional del Litoral (UNL), Facultad de Ingeniería Química, Santiago del Estero 2829, (3000) Santa Fe, Argentina.
3 Universidad Nacional del Litoral-CONICET, Instituto de Desarrollo Tecnológico para la Industria Química, Güemes 3450, (3000) Santa Fe, Argentina. E-mail: zorrilla@intec.unl.edu.ar
INTRODUÇÃO
Diariamente acompanhamos notícias sobre as instabilidades das economias, a destruição ambiental e a degradação social em diferentes países, os quais almejam acelerar suas economias, na expectativa de gerar mais riquezas que possam atender as necessidades de suas populações. O desenvolvimento é, portanto, necessário. No entanto, há necessidade de se respeitar o meio ambiente e as relações de trabalho, pois dependemos disso para garantir o equilíbrio e sobrevivência do planeta. Encontrar um modelo que possa favorecer o desenvolvimento sustentável não é algo simples, pois muitas vezes os interesses econômico, social e ambiental parecem ser antagônicos.
O desenvolvimento sustentável é considerado atualmente o paradigma dominante que guia o planejamento do desenvolvimento mundial (Costa 2010a). Na verdade, por ser uma atividade fornecedora de alimento, fibras, biocombustíveis e outros bens básicos de consumo, a agricultura desempenha um papel central na elaboração de estratégias para a solução dos problemas da humanidade dentro da perspectiva do desenvolvimento sustentável (FAO 2014). Por outro lado, transformar produtos primários em produtos de valor agregado é um desafio indispensável para o desenvolvimento dos países da região.
Neste contexto, o presente capítulo aborda inicialmente alguns aspectos conceituais e o processo de transição para o desenvolvimento sustentável na produção agroalimentar. Em seguida, discute estratégias para implementação da sustentabilidade, bem como metodologias e indicadores adotados na sua avaliação. Por fim, discorre sobre alguns desafios e oportunidades dentro da realidade da América do Sul.
Stadnik MJ, Velho AC, Zorrilla SE (eds.) Desenvolvimento Sustentável na Produção Agroalimentar
3
1. D EFINIÇÃO DE D ESENVOLVIMENTO SUSTENTÁVEL
O conceito de desenvolvimento sustentável foi consagrado no relatório “O Nosso Futuro Comum”, publicado em 1987 pela Comissão Mundial sobre Meio Ambiente e Desenvolvimento das Nações Unidas, chefiada pela então primeira-ministra da Noruega, Gro Harlem Brundtland. O Relatório Brundtland (1987), como ficou conhecido, definia desenvolvimento sustentável como: “(...) o desenvolvimento que satisfaz as necessidades do presente, sem comprometer a capacidade das próximas gerações satisfazerem as suas próprias necessidades”. Isso significa em outras palavras que as pessoas, agora e no futuro, podem apresentar um nível satisfatório de desenvolvimento social e econômico e de realização humana e cultural, fazendo, ao mesmo tempo, um uso racional dos recursos da terra e preservando as espécies e os seus habitats naturais. Portanto, a noção de desenvolvimento sustentável implica em um compromisso de solidariedade com as gerações do futuro, no sentido de assegurar a transmissão do patrimônio capaz de suprir as suas necessidades. Implica também na integração equilibrada dos sistemas econômico, sócio-político e ambiental, e dos aspectos institucionais relacionados com o conceito muito atual de boa governança. Os resíduos sólidos e efluentes líquidos tanto urbanos como rurais constituem em um dos maiores problemas ambientais da atualidade. Os números só fazem crescer e os problemas aparecem com todos os tipos de resíduos. Por outro lado, o interesse por esses materiais orgânicos na agricultura vem chamando atenção do ponto de vista de reciclagem de nutrientes, ambiental e econômico. Por isso, é fundamental adotar políticas públicas e métodos que permitam reciclar os resíduos agropecuários. Neste contexto, os capítulos 10 e 13 deste livro tratam respectivamente da produção de energia renovável e valorização de resíduos orgânicos provenientes do setor agropecuário, enquanto que o capítulo 14 aborda a utilização de resíduos da indústria agroalimentar para o desenvolvimento de biomateriais. Desenvolvimento sustentável é um conceito sistêmico que incorpora os aspectos de um sistema de produção e consumo em massa no qual a preocupação com a natureza deve ser sempre otimizada. Na verdade, existem vários conceitos sobre sustentabilidade. Costa (2010a), após a análise de um conjunto de definições apresentadas na literatura, conclui que (a) é impossível formular uma definição universal de desenvolvimento sustentável (ou sustentabilidade), pois a diversidade de interesses, problemas, perspectivas e escalas relacionadas é muito grande para um consenso; (b) a transição para a sustentabilidade é um processo permanente e dinâmico, pois ela, de fato, nunca será alcançada; (c) a sustentabilidade não se esgota à questão ambiental, como usualmente tem sido associada. Para caracterizá-la é imprescindível ter uma perspectiva global que considere também, os aspectos econômicos e sociais, apesar destes últimos serem, geralmente, negligenciados.
4 DESENVOLVIMENTO SUSTENTÁVEL
A sustentabilidade procura harmonizar três componentes principais da área ambiental, econômica e social, de modo que cada um participe igualitariamente no modelo (Fig. 1). Os componentes (ambiental, econômico e social) interagem por sua vez entre si criando realidades distintas, onde se busca como resultado um desenvolvimento socioeconômico equitativo, socioambiental suportável e econômico-ambiental viável. Por fim, quando os três interagem de modo equilibrado, temos o que chamamos de desenvolvimento sustentável, onde há sustentabilidade ambiental, econômica e sociopolítica (Dalal-Clayton 2019). Em outras palavras, pode-se dizer que o desenvolvimento é ambientalmente (ecologicamente) sustentável quando os recursos naturais são usados de maneira racional, e quando os custos de produção não excedem o seu valor comercial e socialmente justo (equitativo) quando atende às necessidades culturais e materiais das pessoas a longo prazo.

SOCIAL


SAMBIENTAL
ECONÔMICO suportável equitativo

viável
Figura 1. Diagrama representativo do desenvolvimento sustentável, contendo os componentes das áreas ambiental, social e econômica, bem como as qualificações desejadas resultantes de suas interações (interseções). S: Sustentável.
A proteção do meio ambiente e a preservação dos recursos naturais são extremamente importantes na promoção da sustentabilidade das gerações futuras. Assim, a produção de agroalimentos deve respeitar as leis eco-
5 PRODUÇÃO AGROALIMENTAR
lógicas para que a agricultura e o meio ambiente estejam em harmonia. Por outro lado, sociedades sem justiça social e equidade econômica são instáveis e insustentáveis ao longo do tempo. Em geral, tais sistemas são caracterizados pela ocorrência de conflitos sociais que resultam em danos severos aos componentes ambiental e econômico. Por fim, o componente econômico influencia diretamente a atividade e a permanência dos agricultores no meio rural. Para isso, a produção agrária deve promover retornos apropriados, de modo a possibilitar o uso mais eficiente dos recursos disponíveis, a condução a sistemas autossuficientes e viáveis ao longo prazo (Costa 2010a).
2. P ROCESSO DE TRANSIÇÃO PARA O DESENVOLVIMENTO SUSTENTÁVEL
A realização de uma agricultura sustentável tem se mostrado de grande complexidade e ambiguidade, e que em termos práticos somente pode ser implementada gradativamente através de uma série de condições. O desenvolvimento sustentável é a solução que traz paz e segurança, estabilidade econômica e política a nível macro e microrregional. No entanto, a determinação de definições e metodologias operacionais que permitam a aplicação destes conceitos no processo de tomada de decisão tem apresentado uma série de dificuldades, revelando-se uma clara necessidade de aprofundamento da noção dos mesmos. Verifica-se a existência de muitas definições distintas, com pressupostos e dimensões semelhantes, concluindo-se que se tratam de conceitos dinâmicos ainda em construção (Costa 2010a).
De uma forma geral, o desenvolvimento sustentável pressupõe: (a) a preservação do equilíbrio global e das reservas de capital natural; (b) a redefinição dos critérios e instrumentos de avaliação de custo-benefício, de forma que se reflita sobre os efeitos sócio-econômicos e os valores reais do consumo e da conservação; (c) a distribuição e utilização equitativa dos recursos entre as nações e as regiões tanto a nível global como regional.
O processo de transição de agricultura convencional para agricultura sustentável adquire enorme complexidade, tanto tecnológica como metodológica, dependendo dos objetivos e das metas que se estabeleçam, para atingir o nível de transição proposto. Os níveis de transição não são lineares, herméticos ou determinados pelo tempo, sendo necessário entender que se trata de um processo de evolução constante (Abreu et al. 2012).
De acordo com Gliessman (2007), pode-se distinguir quatro níveis fundamentais no processo de transição ou conversão para agroecossistemas sustentáveis. O primeiro diz respeito ao incremento da eficiência das práticas convencionais para reduzir o uso e consumo dos chamados inputs externos, geralmente caros e escassos, e que muitas vezes são nocivos ao meio ambiente. Esta tem sido a principal ênfase da investigação agrária convencional, resultando disso muitas práticas e tecnologias que ajudam a reduzir os impactos negativos desse tipo de agricultura. Como exemplo, pode-se citar os Sistemas
6 DESENVOLVIMENTO SUSTENTÁVEL
de Produção Integrada e as Boas Práticas (Garrido et al. 2004) entre outros, os quais têm contribuído para reduzir o uso de insumos, tais como fertilizantes minerais e de agrotóxicos nas lavouras, diminuindo assim os custos de produção e aumentando a inocuidade dos alimentos colhidos. Discussões referentes à fertilidade do solo e nutrição de plantas são abordadas no capítulo 3, enquanto à inocuidade alimentar se encontram discutidas nos capítulos 15 e 16. Além disso, Boas Práticas Pecuárias são apresentadas no capítulo 9 deste livro. O segundo nível da transição se refere à substituição dos inputs e práticas convencionais por práticas alternativas. A meta seria a substituição de insumos e práticas intensivas por outras mais benignas sob o ponto de vista ecológico. Algumas destas práticas relacionadas ao manejo de doenças e pragas de plantas, bem como ao desenvolvimento de ecofungicidas podem ser encontradas nos capítulos 4 e 7, respectivamente. Neste nível, a estrutura básica do agroecossistema seria ainda pouco alterada, podendo ocorrer, por isso, problemas semelhantes àqueles que se verificam nos sistemas convencionais. Dando prosseguimento, o terceiro e mais complexo nível da transição é representado pelo redesenho dos agroecossistemas, para que estes funcionem em base a um novo conjunto de processos ecológicos. Nesse caso, procura-se eliminar as causas daqueles problemas que não foram resolvidos nos dois níveis anteriores (Gliessman 2000, 2007). Em termos de pesquisa científica, já foram realizados bons avanços em relação à transição do primeiro ao segundo nível, porém os estudos visando alcançar o terceiro nível são recentes e ainda incipientes. Neste livro, os capítulos 10 e 11 contribuem debatendo alguns aspectos dos temas de desenvolvimento territorial sustentável e de paisagens produtivas.
No quarto nível de transição, busca-se restabelecer uma ligação direta entre produtor e consumidor, que também possui sua complexidade e especificidades. Algumas das alternativas de mercado para o desenvolvimento da agricultura familiar encontram-se discutidas no capítulo 18 deste livro. Além disso, aborda-se no capítulo 17 métodos para minimização de perdas na cadeia de produção e comercialização de alimentos. Vale por fim dizer que não há, em termos práticos, impedimento em se trabalhar em mais de um nível de transição simultaneamente.
3. E STRATÉGIAS PARA PRO j ETOS VISANDO A SUSTENTABILIDADE
Estratégias objetivando a sustentabilidade de um sistema deve se converter em desenvolvimento sustentável por meio de objetivos, indicadores, ações e avaliação contínua de resultados. A característica de uma estratégia de sustentabilidade é a sua abordagem em programas comuns definindo inicialmente objetivos, que servem como diretrizes para ações na política e na sociedade, mas sem a força vinculativa de regras comuns, como leis ou regulamentos. Em primeiro plano, há processos de aprendizado e melhoria contínua. A
7 PRODUÇÃO AGROALIMENTAR
estratégia central é criar um modelo de retroalimentação que permite sempre evoluir, ou seja, aperfeiçoar o sistema. O aperfeiçoamento contínuo do sistema é possível graças aos aspectos de tomada de decisão participativa, bem como aos processos de planejamento, implementação e monitoramento das estratégias de sustentabilidade. O monitoramento das ações e dos indicadores previamente selecionados, após a sua sumarização e avaliação, podem conduzir a alterações, as quais fluem então em um novo ciclo (Fig. 2). Os elementos centrais no círculo devem apoiar o desenvolvimento, o que enfatiza tanto o significado especial do processo de pesquisa e aprendizado como também mostra a necessidade de novas formas de participação, comunicação e coordenação das atividades (Masera et al. 2000, FAO 2014, von Hauff 2014). Um ponto central no processo inteiro é a compreensão de que o homem se situa no centro, mas também há necessidades vitais e funções enriquecedoras provenientes das experiências e da natureza.

1.DECISÃO
Avaliação e Priorização
Sumarização dos resultados relevantes


Monitoramento dos indicadores
Comunicação Participação Coordenação Informação
Aprendizagem
Consenso conceitual e delimitação de objetivos

Investimento e seleção de indicadores
Integração geral, controle e estímulo
3. IMPLEMENTAÇÃO

Figura 2. Processo contínuo de aperfeiçoamento de sistemas de produção sustentável, contendo as fases de decisão, planejamento, implementação e monitoramento de estratégias adotadas. Adaptado de von Hauff (2014) e Masera et al. (2000).
8 DESENVOLVIMENTO SUSTENTÁVEL
AMENTO . MONITORAMENTO
2. PLANE j
Novo ciclo
3.1 Indicadores
Avaliar o grau de desenvolvimento sustentável alcançado em um sistema de produção não é uma tarefa simples, porém é essencial para que se possa promover uma agricultura sustentável. Para isso, faz-se necessário conhecer as metodologias e indicadores usados nas avaliações de sustentabilidade que mostrem explicitamente as vantagens e desvantagens ambientais, sociais e econômicas das diferentes estratégias e sistemas de produção.
Um indicador de sustentabilidade ambiental permite a partir de sua interpretação definir se a condição de um sistema de produção é ou não sustentável. Os assim denominados indicadores de sustentabilidade, isolados ou integrados em modelos mais complexos, constituem, portanto, em uma importante ferramenta de avaliação da sustentabilidade (Masera et al. 2000). Eles são encontrados na literatura e vêm sendo usados empiricamente. Entretanto, tanto a identificação dos mesmos como a sua forma de medição podem afetar o valor obtido e a avaliação da sustentabilidade. Neste sentido, Costa (2010c) apresentaram algumas considerações relevantes relativas ao desenvolvimento de indicadores de sustentabilidade, que permitem concluir sobre a infinidade de indicadores passível de serem identificados em diversas metodologias para a avaliação da sustentabilidade, bem como a limitação dos critérios usados quando da sua seleção e medição. De modo geral, pode-se dizer que os indicadores de sustentabilidade devem refletir a integração do desenvolvimento social, ambiental e econômico bem como as suas inter-relações. Os indicadores econômicos existem há várias décadas, mas são insuficientes para determinação do bem-estar social ou do nível de desenvolvimento dos povos. Mais tarde se ampliou esses indicadores em diferentes áreas de desenvolvimento das sociedades, devido à preocupação crescente com a avaliação da sustentabilidade (Marzall e Almeida 2000). De acordo com van Cauwenbergh et al. (2007), os indicadores de sustentabilidade devem descrever aspectos dos agroecossistemas, ou condições de gestão indicativas do estado do sistema de uma forma objetiva e verificável. Trata-se de um importante ponto de partida na gestão de um sistema de exploração. Masera et al. (2000) propõem a seleção de indicadores por uma equipe multidisciplinar, e que esta seja baseada na seleção participativa dos próprios envolvidos da avaliação. Como ainda lembrado por van Cauwenbergh et al. (2007), os indicadores podem mudar com o passar do tempo, em função de novas demandas originadas por novos conhecimentos científicos e/ou por novas preocupações sociais. Nem tudo que influencia a sustentabilidade é um bom indicador (Costa 2010c). Os indicadores descrevem um processo específico e são particulares a esses processos. Portanto, não há um conjunto de indicadores universais que possam ser adotados a qualquer realidade. Os indicadores devem refletir os objetivos delineados no início do processo e serem construídos e monitorados de uma forma participativa (Deponti et al. 2002).
9 PRODUÇÃO AGROALIMENTAR
Costa (2010c) sistematizou alguns dos principais atributos, critérios de diagnóstico, indicadores e índices para avaliação da sustentabilidade dos sistemas agropecuários, dentro das áreas de avaliação ambiental, econômica e social. Os atributos são propriedades inerentes aos sistemas e servem para guiar a análise de aspectos relevantes. Os critérios de diagnóstico, por sua vez, consistem num nível mais detalhado dos atributos. Em sua revisão, o autor classificou um total de 52 indicadores/ índices passíveis de serem utilizados, sendo 19 ambientais, 13 sociais e 20 econômicos; agrupados em 14 critérios de diagnóstico e 5 conjuntos de atributos de sustentabilidade. Por exemplo, no que concerne ao atributo estabilidade/ resiliência, usando o critério de diversidade, pode-se adotar os indicadores/ índices econômicos diversificação de atividades (pluriatividade) e de produtos vendidos, bem como o indicador ambiental diversidade de espécies exploradas.
3.2 Metodologias de avaliação de sustentabilidade Existem diversas propostas metodológicas para avaliar o desempenho em termos de sustentabilidade de países, regiões, locais e, mesmo, sistemas de produção. Essas metodologias podem, no entanto, adotar diferentes abordagens. A maioria desses procedimentos disponíveis leva em consideração principalmente aspectos ambientais, enquanto os aspectos econômicos e sociais são deixados em um segundo plano (Costa 2010b). De um modo geral, pode-se ainda dizer que muitas metodologias usadas têm ainda um certo grau de subjetividade, pois tanto a forma de monitoramento como a seleção dos indicadores não é algo rígido, variando dentro do contexto em que se encontram inseridos. Segundo Marzall e Almeida (2000), as análises de sustentabilidade, mesmo relacionando indicadores que abordam diferentes dimensões, concentram-se nos indicadores e não em suas possíveis interações. A realização de uma análise sistêmica, permitindo o entendimento de quais e como se estabelecem as interações, possibilitaria tirar o melhor proveito delas. O desenvolvimento de metodologias e modelos usados na mensuração da sustentabilidade é algo relativamente recente, apresentando por isso ainda dificuldades para retirar afirmações conclusivas. As principais propostas metodológicas internacionais para avaliar a sustentabilidade da produção de agroalimentos foram sumarizadas e discutidas por Costa (2010b), a saber: (a) SARN - Sostenibilidad de la agricultura y los recursos naturales; (b) FESLM –Framework for evaluation of sustainable land management; (c) MESMIS – Marco para la evaluación de sistemas de manejo de recursos naturales mediante indicadores de sustentabilidad (Masera et al. 2000); (d) KUL – Kriterien umweltvertraglicher landbewirtschftung; ARBRE – Arbre de l’exploitation agricole durable; (e) DIALECTE – Diagnostic agri-envionnmental liat environnement et contrat territorial d’exploition; (f) IDEA – Indicateurs de durabilitie des exploitations agricoles; INDIGO – Indicateurs de diagnostic global a la parcele; (g) DIALOGUE – Diagnostic agri-environmental de l’exploitation agricole; (h) SAFE
10 DESENVOLVIMENTO SUSTENTÁVEL
– Sustainability assessment of farming and the envionment; RISE – Response-inducing sustainability evaluation e SSP – Sustainability solution space. Por fim, o autor conclui que, na maioria dos casos, inexiste qualquer tipo de interação entre essas metodologias quando da sua elaboração, mas que uma visão integral das mesmas seria desejável pois poderia gerar melhores alternativas metodológicas.
4. N OVOS PARADIGMAS NA P RODUÇÃO S USTENTÁVEL DE A LIMENTOS
Paradigma é um conceito das ciências e da epistemologia (a teoria do conhecimento) que define um exemplo típico ou modelo para algo. Em resumo, é a representação de um padrão a ser seguido. Os termos paradigma e mudança de paradigmas se tornou popular após a publicação do livro “A Estrutura das Revoluções Científicas” pelo físico e filósofo da ciência Thomas S. Kuhn, em 1962. Para ele, as realizações científicas são paradigmáticas pois geram modelos que, por períodos mais ou menos longos e de modo mais ou menos explícito, orientam o desenvolvimento posterior das pesquisas exclusivamente na busca de soluções para os problemas por elas criados (Kuhn 1970, Mendonça 2012).
A agricultura é uma atividade que permite não somente produzir alimentos e recursos renováveis, mas também possibilita o desenvolvimento do meio rural. Como consequência, a produção agrária tem desenhado paisagens diversas e de grande beleza e, podendo contribuir para a preservação da biodiversidade através da utilização das terras de uma forma adequada às condições naturais (agricultura tradicional ou familiar) (Costa 2010a). Por outro lado, o aumento exponencial da população, a adoção de políticas agrárias para produção intensiva e o estabelecimento de novos padrões de consumo têm originado um outro tipo de agricultura (agricultura convencional) que vem refletindo negativamente sobre o meio ambiente e as relações sociais existentes no campo. Como consequência, vale destacar o esgotamento dos recursos naturais, a diminuição da biodiversidade e o êxodo rural.
As consequências negativas associadas a esses modelos de produção têm induzido a procura de paradigmas alternativos para o desenvolvimento de uma agricultura que visa a sua sustentabilidade. Como exemplos de novos modelos, movimentos (linhas de pensamento) alternativos ou de agricultura não industrial, vale citar: a Agricultura Biodinâmica, a Agricultura Biológica, a Agricultura Ecológica, a Agricultura Natural, a Agricultura Regenerativa, a Permacultura, entre outros (Assis 2005, Darolt 2002).
De acordo com Darolt (2002), o movimento orgânico representa a fusão de diferentes correntes de pensamento tais como a agricultura biodinâmica, biológica, orgânica e natural. Possivelmente, a origem desse tipo de produção de alimentos seja na Europa. Contudo, somente a partir do início do século XX, esses movimentos começaram a se tomar mais organizados.
11 PRODUÇÃO AGROALIMENTAR
A Agricultura Orgânica baseia-se na melhoria da fertilidade do solo por um processo biológico natural, com uso de matéria orgânica. Marcadamente influenciada pela teoria da Trofobiose (Chaboussou 1987), é totalmente contrária ao uso de agrotóxicos e adubos químicos solúveis. Apresenta um conjunto de normas bem definidas para produção e comercialização da produção determinadas e aceitas a nível nacional e internacional, por meio de um processo de certificação.
A Agroecologia, enquanto disciplina teórica, com uma base integradora das ciências como agronomia, ecologia e outras de caráter socioeconômico analisa os efeitos das tecnologias sobre os sistemas de produção agrícola e a sociedade como um todo (Altieri 1987). Faz a aplicação dos princípios ecológicos no manejo de agroecossistemas sustentáveis (Gliessman 2000). Pode ser entendida também como um novo enfoque científico que reúne e sintetiza conhecimentos de diferentes áreas em uma abordagem sistêmica, com forte componente ético, para geração de novas estratégias para o desenho e manejo de agroecossistemas sustentáveis. Outra abordagem da Agroecologia é como uma ciência capaz de estudar, analisar, desenhar e avaliar agroecossistemas, com objetivo de permitir a implantação de uma agricultura com maior nível de sustentabilidade (Darolt 2002).
Segundo Altieri (1987, 1995) o redesenho dos agroecossistemas e a agrobiodiversidade são fundamentais na Agroecologia, sendo que quatro componentes desempenham um papel central para um agroecossistema sustentável: (a) o uso da cobertura vegetal; (b) o aumento de matéria orgânica no solo para promover atividades bióticas; (c) a aplicação de práticas associadas ao ciclo de nutrientes tais como as rotações, lavouras em consórcio e o uso de leguminosas, etc., e (d) o manejo de pragas e doenças através de controle biológico e da biodiversidade.
A Agroecologia é tratada como um enfoque científico de estudos dos agroecossistemas, mas existem interpretações que não são exclusivas, mas complementares: como aquelas relacionadas ao campo científico, movimento sociais e práticas agrícolas (Wezel et al. 2009). De forma semelhante, Agricultura orgânica não pode ser resumida como um conjunto de práticas certificadas. Todavia, sob o ponto de vista da prática agrícola, onde os agricultores assumem uma atitude pragmática, as noções de Agricultura Orgânica e Agroecologia muitas vezes se confundem (Abreu et al. 2012).
Sistema Agroflorestal ou Agrofloresta se constitui em um sistema que reúne culturas de importância agronômica consorciadas com a floresta. Um sistema agroflorestal é um sistema de produção de alimentos que é sustentável em termos ecológicos, e ainda faz a recuperação de uma floresta (Laura et al. 2015). As agroflorestas representam sistemas de uso e ocupação do solo em que plantas lenhosas perenes (árvores e arbustos) pertencentes às mais variadas espécies, são manejadas em consórcios com plantas herbáceas, culturas agrícolas e/ou forrageiras e/ou em integração com animais, em uma mesma
12 DESENVOLVIMENTO SUSTENTÁVEL
área, de acordo com um arranjo espacial predefinido, ocorrendo inúmeras interações ecológicas entre os elementos da composição do sistema, caracterizando assim um modelo agroecológico de sistema integrado (Laura et al. 2015, Miccolis et al. 2016).
Apesar da crescente utilização do uso de Sistemas Agroflorestais em países da América do Sul, por conta da busca por um sistema de exploração agrícola sustentável em que se possa produzir alimentos sem prejuízos ao meio ambiente, é necessário estudar uma melhor adequação técnica dos modelos escolhidos às inúmeras realidades presentes no subcontinente. Neste sentido, são apresentadas no capítulo 8 algumas experiências de sistemas agroflorestais e silvo pastoris aplicadas na região de Córdoba, Argentina.
Em resumo, o ideal compartilhado entre as diferentes correntes que formam a base da agricultura orgânica/ agroecologia é a busca de um sistema de produção sustentável no tempo e no espaço, mediante o manejo e a proteção dos recursos naturais, sem a utilização de produtos químicos agressivos à saúde humana e ao meio ambiente, mantendo o incremento da fertilidade e a vida dos solos, a diversidade biológica, bem como respeitando a integridade cultural dos agricultores.
A transição para sistemas de produção agroecológica deve considerar que nem todos os sistemas em transição são altamente produtivos, pois muitos deles envolvem agricultores tradicionais. Segundo Dal Soglio (2016), esses agricultores com baixa produtividade média, mesmo adotando técnicas modernas, não lograriam produtividade elevada. Nesses casos, a transição para modelos de base ecológica significaria incrementos significativos de produtividade. Por outro lado, além da produtividade, outros fatores, entre os quais a sustentabilidade ambiental, a equidade, a autonomia e a estabilidade, também deveriam ser objeto de comparação.
5. D ESAFIOS E OPORTUNIDADES PARA O D ESENVOLMENTO S USTENTÁVEL NA A MÉRICA DO S UL
Em um mundo globalizado, onde o livre comércio permite que alimentos sejam importados rapidamente e a baixo custo, os produtores rurais se encontram numa situação econômica bastante instável e vulnerável. Os preços de seus produtos já não mais estabelecidos apenas pelos consumidores locais, mas agora por mercados e bolsas de valores longínquos, os quais favorecem a competição com o objetivo de oferecer cada vez mais produtos de qualidade a baixo custo. Ao longo de sua história, a América do Sul vem sofrendo ondas de instabilidade política e econômica, que atingem seus países com maior ou menor impacto. Se não bastassem as vicissitudes econômicas, somam-se as ameaças ambientais devido às mudanças climáticas. Dentro deste cenário, a busca pelo desenvolvimento sustentável pode contribuir não somente para melhorar a qualidade de vida de seus habitantes e mitigar os danos ambien-
13 PRODUÇÃO AGROALIMENTAR
tais, mas também construir uma nova realidade de esperança para as futuras gerações.
Com aproximadamente 12% da superfície terrestre e 6% da população mundial, a América do Sul é um subcontinente que envolve a parcela meridional do continente americano, com aproximadamente quatro quintos abaixo da Linha do Equador. Seu território é marcadamente caracterizado ao oeste, pela longa e imponente cadeia montanhosa dos Andes, que chega acima de 6.000 m de altitude em alguns pontos. Neste imenso território, localiza-se predominantemente ao norte, a densa e úmida Floresta Amazônica, enquanto na área central predominam os terrenos alagados que abarcam o Pantanal brasileiro, e o Gran Chaco. Ao centro-sul, planícies (Pampa) e cerrados, enquanto na costa leste, os resquícios da floresta atlântica, que desapareceu quase por completo para favorecer a ocupação industrial e agrícola.
Na América do Sul, devido as condições climáticas, de relevo e de colonização, há uma distribuição populacional desigual no território. Existem áreas muito povoadas, como aquelas localizadas na faixa litorânea voltada, assim como nos planaltos localizados nos Andes Centrais e Setentrionais. Por outro lado, existem áreas pouco habitadas, como aquelas de clima árido, como no Deserto do Atacama, e de clima frio de montanha, como nos Andes. São ainda pouco habitadas também as áreas de floresta equatorial. Contudo, devido ao papel fundamental na regulação climática global, o desmatamento destas áreas tem colocado em risco não somente a sobrevivência a longo prazo das populações locais, mas também de populações situadas em regiões distantes. A conservação desse Bioma com a maior biodiversidade terrestre do mundo não deve ser vista somente como um desafio, mas sim como uma oportunidade para aplicar os conhecimentos de desenvolvimento sustentável (Assad 2016). Lá existem inúmeras espécies vegetais que podem ser exploradas de modo racional e contribuir para a solução de vários problemas da humanidade. A população sul-americana possui uma composição étnica diversa originada de povos pré-colombianos e de imigrantes que ao longo dos séculos vêm se miscigenando em maior ou menor grau dentro de cada território e país, criando um mosaico de culturas e realidades. Como consequência, o subcontinente é rico em conhecimento tradicional acumulado ao longo de sua história. A revalorização de produtos vegetais pode ser incrementada quando a ciência contribui na análise desse tipo de conhecimento. Neste sentido, os capítulos 5 e 6 trazem à luz as experiências do cultivo de chás e plantas medicinais na região oeste do Paraná (Brasil) e do Nordeste Argentino, respectivamente. A América do Sul possui características bastante variadas, tanto em seus aspectos físicos e climáticos, quanto culturais. Essa diversidade possibilita a produção de alimentos com características especiais, as quais podem ser exploradas comercialmente a fim de permitir aos agricultores uma maior valorização de seus produtos. O capítulo 12, sobre queijos artesanais, exemplifica essa oportunidade que está sendo colocada em prática na Argentina e Brasil.
14 DESENVOLVIMENTO SUSTENTÁVEL
Quanto ao clima, estão presentes no subcontinente os climas equatorial, tropical subtropical e temperado. Contudo, existem particularidades climáticas na América do Sul por conta das condições do seu relevo, como o clima frio de montanha e ainda o semiárido, bem como o desértico. A América do Sul possui uma ampla abundância de recursos hídricos, no qual estão presentes importantes bacias hidrográficas, como a Bacia Amazônica e a Bacia Platina. Os rios que formam a Bacia Amazônica drenam a maior parte dos territórios dos países sul-americanos, sendo que o principal rio da bacia é o rio Amazonas, o qual nasce nos Andes e percorre mais de 6000 Km até chegar ao Oceano Atlântico. Em relação à Bacia Platina, o rio de principal é o Rio Paraná. Em função da disponibilidade hídrica e das condições climáticas variadas na América do Sul, existem muitos tipos de vegetação no subcontinente. Há uma enorme biodiversidade muito pouco explorada ainda e que merece atenção especial no sentido de preservá-la e utiliza-la de modo sustentável. O capítulo 2 discute alguns fundamentos relacionados à implantação e manejo de agroecossistemas com vistas à conservação da biodiversidade. Bioma pode ser considerado uma unidade biológica dentro de um espaço geográfico cujas características específicas são definidas pelo macroclima, fitofisionomia, altitude, solo e outros fatores. É um conjunto de ecossistemas, habitats ou comunidades biológicas com certo nível de homogeneidade. As classificações dos biomas variam, entretanto, de autor para autor, e mesmo de país para país. Na literatura biogeográfica Brasileira (incluindo trabalhos do IBGE e Embrapa), o termo “bioma” é muitas vezes usado como sinônimo de “província biogeográfica”, uma área determinada com base na sua composição taxonômica de espécies autóctones, e vem sendo aplicados às áreas da Amazônia, Caatinga, Cerrado, Mata Atlântica, Pampa e Pantanal (IBGE 2019), mas que estão inclusos em outras denominações de biomas terrestres de acordo com o uso de tal termo na literatura internacional (McGinley 2014). Apesar de nomes ou classificações diferentes adotadas, muitos dos biomas são compartilhados por diferentes países sul americanos. Por exemplo, a Amazônia ocupa além do território brasileiro, as Guianas, Suriname, Venezuela, Equador, Peru e Bolívia; o Chaco é um grande bioma de floresta seca no centro da América do Sul, e que ocupa uma vasta planície entre o norte da Argentina, o Paraguai e a Bolívia, mas também invade porções dos estados brasileiros do Mato Grosso e do Mato Grosso do Sul que margeiam as áreas semi-alagadas do Pantanal; o Pampa está presente na Argentina e no Uruguai, mas também no Sul do Brasil; e muitos outros. Contudo, em termos de exploração sustentável, ainda são poucas as trocas de experiências entre os países que compartilham biomas comuns. Neste livro, o capítulo 6 apresenta plantas medicinais e aromáticas do nordeste argentino, mas que também ocorrem nos países limítrofes daquela região e em países vizinhos
15 PRODUÇÃO AGROALIMENTAR
C ONSIDERAÇ õ ES F INAIS
A aplicação dos conceitos de sustentabilidade é influenciada por uma dinâmica de componentes sócio-econômicos, ambiental, político cultural, em uma escala espacial e temporal variável. Em uma região continental como a América do Sul existem diferentes realidades que, se por um lado oferecem grandes desafios na concepção de modelos adequados de desenvolvimento, permitem por outro lado encontrar oportunidades inovadoras para a solução dos problemas locais e macrorregionais. A conciliação da exploração agropecuária e florestal com a preservação ambiental é uma tarefa complexa, pois envolve diversos componentes inseridos em realidades distintas. Porém, faz-se necessária para que se garanta o uso dos recursos da natureza pelas futuras gerações na América do Sul, contribuindo tanto para manter a população rural no campo com qualidade de vida, como também para criar um ambiente de estabilidade econômica e social na região.
R EFER ê NCIAS BIBLIOGRÁFICAS
Abreu LS, Bellon S, Bradenburg A, Ollivier O, Lamine C, Darolt MR, Aventurier P (2012) Relações entre agricultura orgânica e agroecologia: desafios atuais em torno dos princípios da agroecologia. Desenvolvimento e Meio Ambiente, 26: 143-160.
Altieri MA (1987) Agroecology: the scientific basis of alternative agriculture. Boulder, CO: Westview Press, 227p.
Altieri MA (1995) El “estado del arte” de la agroecología y su contribución al desarrollo rural en América Latina. In: CADENAS MA (Org.). Agricultura y desarrollo sostenible. Madrid: MAPA, pp.151-2013.
Assad ED (2016) Amazônia legal: propostas para uma exploração agrícola sustentável (relatório completo). EESP-Escola de Economia de São Paulo, 34p. http://bibliotecadigital.fgv.br/dspace/handle/10438/17673. Acesso 10 de outubro de 2019.
Assis RL (2005) Agricultura orgânica e agroecologia: questões conceituais e processo de conversão. Documentos, 196, Embrapa Agrobiologia: Seropédica, 35 p.
Chaboussou F (1987) Plantas doentes pelo uso de agrotóxicos: a teoria da trofobiose. Porto Alegre: L&PM. 256 p.
Costa AAVMR (2010a) Agricultura sustentável I: Conceitos. Revista de Ciências Agrárias, 33(2): 61-74.
Costa AAVMR (2010b) Agricultura sustentável II: Avaliação. Revista de Ciências Agrárias, 33 (2): 75-89.
Costa AAVMR (2010c) Agricultura sustentável III: Indicadores. Revista de Ciências Agrárias, 33(2): 90-105.
Dalal-Clayton B (2019) What is sustainable development? http://www.nssd. net/pdf/sustdev2.pdf Acesso em 15 de outubro de 2019.
16 DESENVOLVIMENTO SUSTENTÁVEL
Dal Soglio F (2016) A Agricultura moderna e o mito da produtividade. In:Dal Soglio F, Kubo RR (2016) Desenvolvimento, agricultura e sustentabilidade. Editora da UFRGS, Porto Alegre, pp. 11-38.
Darolt MR (2002) As principais correntes do movimento orgânico e suas particularidades. In: Darolt MR. Agricultura orgânica: inventando o futuro. Londrina: IAPAR, pp. 18-26.
Deponti CM, Eckert C, Azambuja JLB (2002) Estratégia para construção de indicadores para avaliação da sustentabilidade e monitoramento de sistemas. Agroecologia e Desenvolvimento Rural Sustentável, 3(4): 44-52.
FAO (2014) Building a common vision for sustainable food and agriculture. Principles and approaches, Roma, 56 p. http://www.fao.org/3/a-i3940e. pdf. Acesso 10 de outubro de 2019.
Garrido LR, Sônego OR, Valdebenito-Sanhueza RM (2004) Controle racional de doenças da macieira. In: Stadnik, MJ & Talamini V, Manejo Ecológico de Doenças de Plantas, Florianópolis, UFSC, pp. 17-30.
Gliessman SR (2000) Agroecologia: processos ecológicos em agricultura sustentável. Porto Alegre: Editora da Universidade - UFRGS, 653p.
Gliessman SR (2007) Agroecology: the ecology of sustainable food systems. New York: CRC Press, 406p.
IBGE (2019) Biomas. https://www.ibge.gov.br/geociencias/informacoes-ambientais/15842-biomas.html?=&t=o-que-e. Acesso em 02 de novembro de 2019.
Kuhn TS (1970) The Structure of Scientific Revolutions. 2 ed., enlarged. Chicago and London: University of Chicago Press, 264 p.
Laura VA, Alves FV, Almeida RG (2015) Sistemas agroflorestais: a agropecuária sustentável – Brasília : Embrapa, 208 p.
Masera Ó, Astier M, López-Ridaura S (2000) Sustentabilidad y manejo de recursos naturales. El marco de evaluación MESMIS. GIRA A.C. Mundi-Prensa, México, 109 p.
Marzall K, Almeida J (200) Indicadores de sustentabilidade para agroecossistemas. Estado da arte, limites e potencialidades de uma nova ferramenta para avaliar o desenvolvimento sustentável. Cadernos de Ciência & Tecnologia 17(1): 41-59.
McGinley M. 2014. Biome. http://editors.eol.org/eoearth/wiki/biome. Acesso 08 de novembro de 2019
Mendonça ALO (2012) O legado de Thomas Kuhn após cinquenta anos. Scientiae Studia, 10 (3):535-560. http://dx.doi.org/10.1590/S167831662012000300006. Acesso 16 de outubro de 2019.
Miccolis A et al. (2016) Restauração Ecológica com Sistemas Agroflorestais: como conciliar conservação com produção. Opções para Cerrado e Caatinga. Brasília: Instituto Sociedade, População e Natureza – ISPN/Centro Internacional de Pesquisa Agroflorestal – ICRAF, 266 p. van Cauwenbergh N, Biala K, Bielders C, Brouckaert V, Franchois L, Garcia Cidad V, Hermy M, Mathijs E, Muys B, Reijnders J, Sauvenier X, Valckx J, Vanclooster M, Van der Veken B, Wauters E, Peeters A (2007) - SAFE – A hierarchical framework for assessing the sustainability of agricultural systems. Agriculture, Ecosystems and Environment 120: 229-242.
17 PRODUÇÃO AGROALIMENTAR
von Hauff M (2014) Nachhaltige Entwicklung. Gundlagen und Umsetzung. De Gruyter, Oldenbourg, pp. 282.
Wezel A, Bellon S, Doré T, Francis C, Vallod D, David C (2009) Agroecology as a science, a movement and a practice. A review. Agronomy for Sustainable Development, 29(4): 503-515.
18 DESENVOLVIMENTO SUSTENTÁVEL
CONSERVAÇÃO DA BIODIVERSIDADE NOS
AGROECOSSISTEMAS
Renata Evangelista de Oliveira1 & Luiz Fernando D. de Moraes2
1 Universidade Federal de São Carlos ( UFSCAR ), Centro de Ciências Agrárias, Departamento de Desenvolvimento Rural, Rodovia Anhanguera, km 174, 13.600-970, Araras-SP, Brasil. E-mail: reolivei@ufscar.br
2 Centro Nacional de Pesquisas em Agrobiologia (CNPAB) da Embrapa, Rodovia BR 465, km 7, 23891-000, Seropédica-RJ, Brasil. E-mail: luiz.moraes@embrapa.br
INTRODUÇÃO
Uma grande proporção dos ecossistemas atualmente degradados, danificados ou destruídos são terras agrícolas, resultado de um processo histórico em que o avanço da agricultura causou a fragmentação, a degradação e a alteração de muitos ecossistemas naturais. Por isso, há que se pensar em uma forma diferente de se fazer agricultura, em que os agroecossistemas possam contribuir com a conservação da biodiversidade e a garantia de serviços ecossistêmicos.
Este capítulo busca dialogar com essa nova perspectiva, e traz conceitos relacionados à estrutura e funcionamento de agroecossistemas, bem como às diferentes “diversidades” que esses sistemas, tão distintos ao longo das múltiplas paisagens rurais existentes, podem ajudar a conservar. Traz a discussão sobre possíveis bases fundamentais e estratégias relacionadas à implantação e manejo desses agroecossistemas com vistas à conservação da biodiversidade e à provisão de serviços ecossistêmicos, e enfatiza a participação social, a valorização do conhecimento tradicional e o desenvolvimento de práticas agroecológicas nesses processos.
1. DESENVOLVIMENTO SUSTENTÁVEL, BIODIVERSIDADE, PAISAGENS RURAIS E AGROECOSSISTEMAS
Os principais esforços para a conservação da biodiversidade em nível global são coordenados pela Convenção sobre a Diversidade Biológica - CDB (Brasil, 1998), compromisso assinado por 168 países entre 1992 e 1993, no contexto da Conferência das Nações Unidas sobre o Meio Ambiente e o Desenvolvimento (ECO 92). Os objetivos da CDB são “a conservação da diversidade biológica, a utilização sustentável de seus componentes e a repartição justa e
Stadnik MJ, Velho AC, Zorrilla SE (eds.) Desenvolvimento Sustentável na Produção Agroalimentar
19
2
equitativa dos benefícios que se derivem da utilização dos recursos genéticos”. As diretrizes sobre o acesso aos recursos genéticos e a participação equitativa de benefícios têm seu marco regulatório reforçado pelo Protocolo de Nagoya. Complementarmente, o Protocolo de Cartagena aborda a biossegurança, alertando para os riscos à conservação da biodiversidade proporcionados por tecnologias que manejam organismos vivos.
Mais recentemente, a agenda da Organização das Nações Unidas para o Desenvolvimento Sustentável (ONU 2015) prevê, dentre seus trinta objetivos, dois que se relacionam diretamente à agricultura e seus efeitos, que são “acabar com a fome, alcançar a segurança alimentar e melhorar a nutrição e promover a agricultura sustentável”; e “proteger, restaurar e promover o uso sustentável de ecossistemas terrestres (com destaque ao manejo florestal sustentável) combater a desertificação, deter e reverter a degradação das terras e deter a perda de biodiversidade”. Para atingir esses objetivos há que se repensar a forma de se fazer agricultura (Boody e DeVore 2009, Landis 2017, Knickel et al. 2018), e criar inovações nos manejos e na construção de novos arranjos produtivos em paisagens rurais. A área ocupada com agricultura no mundo cresceu 12% nos últimos 50 anos, hoje é de 1,6 bilhões de hectares (FAO 2011). As culturas agrícolas e pastagens são a forma preponderante de uso da terra em aproximadamente 40% da área do planeta (Barral et al. 2015), e têm sido, historicamente, grandes impulsionadoras da perda de biodiversidade. As formas como a agricultura convencional afeta as espécies, são bastante complexas, e incluem a conversão de ecossistemas naturais em áreas agrícolas, a intensificação do manejo em paisagens culturais de longa data e a liberação de substâncias poluentes, entre outras (Dudley et al. 2017, Dudley e Alexandre 2017).
Conciliar demandas por alimentos e a necessidade de garantia de serviços ecossistêmicos é um dos nossos grandes desafios e, nesse ínterim, a biodiversidade é um dos pilares para a agricultura sustentável, a segurança alimentar e a saúde (Kazemi et al. 2018). O desenvolvimento dessa agricultura sustentável deve envolver a manutenção do equilíbrio entre a função produtiva, econômica e social das paisagens agrícolas e suas funções ecológicas. São necessárias estratégias voltadas a reduzir ou eliminar a perda de ecossistemas nativos, manter a diversidade genética de plantas e animais cultivados e de seus parentes silvestres, reconhecer a importância dos conhecimentos tradicionais e práticas de comunidades locais para a conservação e o uso sustentável da biodiversidade, e garantir que as áreas sob agricultura sejam manejadas a fim de se conservar a biodiversidade nas paisagens rurais (FAO 2019). Os elementos básicos, formadores dessas paisagens, são os agroecossistemas. Os agroecossistemas são locais de desenvolvimento de múltiplas ações, de cultivo e criação de espécies, extrativismo e manejo, em diferentes modelos de agricultura. Podem contemplar características diversas quanto à composição de espécies e seus arranjos e modelos, quanto á dinâmica espa-
20 DESENVOLVIMENTO SUSTENTÁVEL
cial e temporal das práticas de manejo, ter objetivos distintos e estar inseridos em múltiplas paisagens, com diferentes características culturais, históricas, estruturais e dinâmicas (Gliessman 2009, Santos et al. 2007, Flores et al. 2016). Dependendo da composição, complexidade e tipo e intensidade de manejo realizado nos agroecossistemas, estes são capazes de prover todo um conjunto de bens e serviços, e apresentar um maior ou menor potencial de conservação da biodiversidade.
2.APORTES CONCEITUAIS
2.1
Sobre a Biodiversidade e Conservação
A Diversidade Biológica (ou Biodiversidade) é a riqueza da vida na Terra, incluindo milhões de plantas, animais e microrganismos, os genes que eles contêm e os ecossistemas que constroem no ambiente. Pode também ser definida como a variedade da vida nos níveis de genes, de espécies e de ecossistemas. Comporta toda a variabilidade existente entre os organismos vivos (dentro e entre espécies) e os ecossistemas dos quais fazem parte (FAO 2019). Os sistemas agrícolas existentes no mundo se inserem na diversidade dos biomas, ecossistemas e culturas, e na história da domesticação de plantas e animais (Semeghini et al. 2017). Relacionados ao manejo desses sistemas estão atrelados alguns conceitos fundamentais e dimensões relacionados à diversidade, tais como:
Agrobiodiversidade: A Convenção sobre a Diversidade Biológica (Brasil 1998) a define como um termo amplo que inclui todos os componentes relevantes da biodiversidade que constituem os agroecossistemas. O termo referese à biodiversidade de agroecossistemas, juntamente com espécies de culturas e animais de criação, a variação genética dentro das populações e respectivas variedades e raças. Compreende os componentes genéticos, populacionais, de espécies, comunidades, ecossistemas e paisagens e as interações humanas com todos estes, e também inclui os habitats e espécies fora dos sistemas agrícolas que beneficiam a agricultura e melhoram as funções do ecossistema. (Jackson et al. 2005, Kazemi et al. 2018).
Para Zimmerer (2014) são quatro os seus principais componentes: (1) recursos genéticos para alimentação e agricultura, (2) biodiversidade que apoia os serviços ecossistêmicos da agricultura, (3) fatores abióticos, como o clima e (4) dimensões socioeconômicas e culturais. Jackson et al. (2005) citam como exemplos de componentes da agrobiodiversidade as características genéticas e populacionais de variedades tradicionais, raças e espécies silvestres relacionadas, que são importantes para a adaptação humana às mudanças socioeconômicas e ambientais; agenciamentos comunitários que limitam os danos causados pelas pragas às culturas, e o habitat do qual eles dependem; as funções do ecossistema, como ciclagem de nutrientes e retenção, que são derivadas da biodiversidade espacial e temporal por meio de rotações, pousio e
21 CONSERVAÇÃO DA BIODIVERSIDADE
plantio direto; e interações no nível da paisagem entre ecossistemas agrícolas e não agrícolas que aumentam a disponibilidade de recursos para a agricultura.
Sociobiodiversidade: É um conceito que abarca a inter-relação entre a diversidade biológica e a de sistemas socioculturais. Refere-se a produtos manejados por populações humanas, com base em conhecimentos locais e garantindo sua subsistência (Fé e Gomes 2015). A sociobiodiversidade diz respeito a conhecimentos, culturas e modos tradicionais de vida e de apropriação da natureza, que podem ser a base para a construção de novos modelos de ocupação, produção e geração de riqueza (Mazzetto Silva et al. 2009). Atividades como o extrativismo vegetal e o agroextrativismo refletem essa diversidade. O agroextrativismo une práticas agrícolas sustentáveis, de baixo impacto e alto valor social, com a extração de produtos nativos (Carvalhaes e Oliveira 2017).
Biodiversidade para alimentação e agricultura (FAO 2019): É o subconjunto da biodiversidade que contribui de uma forma ou de outra para a agricultura e a produção de alimentos. Inclui as espécies de plantas e animais domesticados criados em sistemas agrícolas, pecuários, florestais e de aquacultura, os parentes silvestres de espécies domesticadas, outras espécies selvagens colhidas para alimentação e outros produtos. Abrange também o que é conhecido como “biodiversidade associada”, a vasta gama de organismos (plantas, animais e microrganismos) que vivem dentro e em volta dos sistemas de produção de alimentos e agricultura, sustentando-os e contribuindo para sua produção, com o desenvolvimento e provisão de serviços como polinização, proteção contra eventos climáticos extremos, conservação e manutenção da qualidade da água e dos solos. Por fim, inclui ainda os microrganismos utilizados no processamento de alimentos e em vários processos agroindustriais. Quanto à conservação, também cabem alguns conceitos:
Conservação in situ: conservação dos ecossistemas e habitats naturais e a manutenção e a recuperação de populações viáveis de espécies em seus ambientes naturais e, no caso de espécies vegetais cultivadas ou domesticadas, no ambiente em que desenvolveram suas propriedades características (Conceito firmado pela Convenção da Biodiversidade e pelo Tratado Internacional sobre Recursos Fitogenéticos – Brasil 1998, Brasil 2008).
Conservação ex situ: conservação de recursos fitogenéticos para a alimentação e a agricultura, fora de seu habitat natural (Brasil 2008). Como a “Conservação in situ” muitas vezes é associada à conservação de espécies em seus ambientes naturais, utiliza-se também o termo Conservação on farm para espécies domesticadas, manejadas por agricultores. Para Santilli (2012), com a conservação “on farm” reconhece-se o papel que os agricultores e comunidades locais desempenham na conservação da Agrobiodiversidade.
2.2. Sobre Agroecossistemas
Partiremos inicialmente de três enfoques para o conceito de agroecossistemas, para iniciar nossa discussão sobre o papel desses sistemas na conser-
22 DESENVOLVIMENTO SUSTENTÁVEL
vação da biodiversidade. A partir desses conceitos, podemos elencar algumas informações importantes.
Agroecossistemas são locais de produção agrícola compreendidos como ecossistemas (Gliessman 2009): A premissa é a de que nossa compreensão sobre os ecossistemas naturais proporciona a base segundo a qual podemos analisar os sistemas de produção de alimentos (no tocante aos seus níveis de organização ecológica, estrutura e funcionamento).
Agroecossistemas são ecossistemas cultivados socialmente geridos (Petersen et al 2017): A forma de se compreender os agroecossistemas envolve o enfoque nos processos de intercâmbio de matéria e energia entre as esferas natural e social.
Agroecossistemas são sistemas ecológicos modificados por seres humanos para produção agrícola (Conway 1987): Os agroecossistemas, com diferentes níveis de complexidade, são substitutos de sistemas naturais. Agroecossistemas são sistemas funcionais, onde interagem componentes bióticos e abióticos, dentro de fronteiras arbitrárias. As características gerais para descrição de qualquer agroecossistema referem-se a fatores físicos, biológicos, culturais e socioeconômicos e incluem os recursos presentes (recursos naturais, humanos, e de capital). Como em qualquer ecossistema, vários processos estão relacionados à estrutura, dinâmica e funcionamento (processos energéticos, biogeoquímicos, hídricos e de equilíbrio biótico) desses sistemas. São sistemas mais simplificados que ecossistemas naturais, e sua complexidade surge sobretudo da interação entre processos socioeconômicos e ecológicos. O nível de intervenção humana é variável, bem como a composição de espécies, o que lhes confere mais ou menos complexidade. Obviamente, sistemas mais biodiversos tendem a ser mais complexos e heterogêneos. O estudo dos agroecossistemas, assim como o de ecossistemas naturais, pode ser feito a partir de seus níveis de organização, desde uma planta ou animal inseridos no sistema produtivo (entendidos como indivíduos ou organismos), passando pelo conjuntos de indivíduos da mesma espécie (populações) ou de mais de uma espécie (comunidades) cultivados (no caso de plantas) ou criados (no caso de animais) em um mesmo espaço. A observação desses níveis de organização pode ser feita em diferentes escalas, ou seja, podemos organizar os agroecossistemas em uma escala hierárquica, desde a parcela produtiva dentro de uma propriedade até uma região ou território. Cabe ressaltar que a conservação da biodiversidade também pode ser pensada nessas diferentes escalas, referindo-se a diferentes componentes (ou níveis) dentro dos agroecossistemas e nas paisagens onde estão inseridos.
A Figura 1 traz um quadro comparativo entre agroecossistemas e ecossistemas naturais, no tocante às suas principais características e escalas observáveis, a partir de seus níveis de organização. Considerando as escalas sob as quais podem ser observados e planejados os agroecossistemas, é importante compreendê-los também sob a ótica dos chamados sistemas socioecológicos.
23 CONSERVAÇÃO DA BIODIVERSIDADE

Figura 1. Esquema comparativo entre agroecossistemas e ecossistemas naturais (baseado em Conway 1987, Gliessman 2009, Arnesto et al. 2007). Nas escalas hierarquicamente acima estão níveis de organização mais amplos (regional, nacional e global). Os sistemas de subsistência (agricultura e pecuária) estão associados a modos de vida das comunidades rurais e se inserem em microbacias, regiões, territórios, etc.
24 DESENVOLVIMENTO SUSTENTÁVEL
Sistemas socioecológicos são sistemas complexos, integrados e adaptativos (Resilience Alliance 2010), nos quais seres humanos são parte integrante e onde interagem componentes culturais, políticos, sociais, econômicos, ecológicos e tecnológicos. O conceito de sistemas socioecológicos, como o conceito de agrobiodiversidade, destaca a importância de se integrar a gestão dos recursos naturais com as pessoas (Buschbacher 2014). Quando se estuda a agricultura, a escala focal é a escala da propriedade rural e o agroecossistema nela estabelecido, a microescala remete às pessoas inseridas nas propriedades e nos subsistemas de uso e manejo ali inseridos. A macroescala pode ser representada pela comunidade, município, região e nação, tanto nos sistemas sociais como nos sistemas ecológicos, e existem inter-relações entre as diferentes escalas espaciais (Figueiredo et al. 2017).
É importante destacar que as relações humanas são um fator fundamental para o manejo adequado dos agroecossistemas e para a conservação da biodiversidade nessas diferentes escalas. Nesse ínterim, o conhecimento tradicional e o conhecimento tradicional associado são fatores importantes e devem ser encarados como recursos a serem conservados, tanto quanto a diversidade em si. Para Santilli (2012), as diferenças entre a diversidade silvestre e a diversidade cultivada devem inclusive ser relativizadas, porque a biodiversidade não pode jamais ser reduzida apenas a um fenômeno natural, já que é também um fenômeno cultural. E Semeghini et al. (2017) lembram que a agrobiodiversidade é fruto do manejo complexo e dinâmico de cultivos agrícolas realizados por muitas gerações de agricultores.
3. CONSERVAÇÃO DA DIVERSIDADE EM AGROECOSSISTEMAS E PAISAGENS
A conservação da biodiversidade na paisagem rural com a adoção dos agroecossistemas passa, como já vimos, por compreender como o desenho desses agroecossistemas utiliza a compreensão sobre os processos ecológicos observados em ecossistemas naturais. Se um dos papeis essenciais dos ecossistemas naturais é a provisão de serviços para a paisagem e para a sociedade, a conservação da biodiversidade pela adoção de agroecossistemas deve prever igualmente a provisão de serviços ecossistêmicos. Destacamos, portanto, a importância da aplicação do conhecimento abrigado nas teorias ecológicas clássicas na construção de agroecossistemas e na adoção de práticas agroecológicas, inserindo funções que viabilizem a entrega desses serviços. Na Figura 2, a biodiversidade, para além da riqueza de espécies, representa todo um conjunto de funções relacionadas à provisão de serviços ecossistêmicos responsáveis por conferir resiliência aos ecossistemas naturais e sustentabilidade aos agroecossistemas. Para Sayer et al. (2013) conciliar agricultura e conservação requer o enfoque na paisagem. Esse enfoque requer pensar/planejar sua estrutura, composição e dinâmica em múltiplas escalas e almejar multifuncionalidade,
25 CONSERVAÇÃO DA BIODIVERSIDADE
entre outros aspectos. Paisagens multifuncionais são, conceitualmente, heterogêneas, dado que a heterogeneidade aumenta suas resiliência e sustentabilidade (Gillson 2015). As paisagens multifuncionais devem proporcionar segurança alimentar, possibilitar a criação de animais para alimentação humana e a manutenção de espécies e funções ecológicas, além de prover serviços estéticos e culturais (O’Farrell e Anderson 2010). Sua implantação efetiva demanda, portanto, um esforço transdisciplinar, e o envolvimento de todos os atores em um processo contínuo de aprendizagem e transparência, no estabelecimento de direitos e responsabilidades compartilhadas (Sayer et al. 2013, O’Farrell e Anderson 2010).

Figura 2. Relação entre funções e provisão de serviços ecossistêmicos a partir da estrutura e da biodiversidade de ecossistemas naturais e agroecossistemas (Adaptado de Landis 2017).
Os agroecossistemas, a partir de sua estrutura e tipo de manejo, contribuem com a conservação da biodiversidade em nível local e como componente das paisagens multifuncionais. Dentro de seus limites, ações individuais e coletivas de manejo são implementadas e, sob essas condições, esses agroecossistemas interagem com os ecossistemas circundantes/adjacentes em múltiplas escalas, desde a escala local até o contexto regional, a partir de fluxos de energia, matéria e organismos. Os processos ecológicos, envolvendo tanto a biodiversidade domesticada quanto a silvestre, incluem indivíduos e populações, e se estendem a uma dinâmica de interações ao longo de toda a paisagem (Lescourret et al. 2015).
26 DESENVOLVIMENTO SUSTENTÁVEL
Assim, embora existam limites arbitrários para definir a abrangência do agroecossistema (limites da propriedade ou dos sistemas de cultivo, por exemplo), essas fronteiras são meramente teóricas, os fluxos acontecem dentro e para além dos limites dos agroecossistemas, na paisagem circundante. Isso torna claro o quanto o planejamento da composição e as ações de manejo nos agroecossistemas têm efeito direto nas paisagens multifuncionais onde se inserem, e como colaboram com a provisão de múltiplos serviços ecossistêmicos (Fig 3).

Figura 3. Influência da combinação entre as características de ecossistemas naturais e as demandas da sociedade na definição de manejo de agroecossistemas e os potenciais serviços ecossistêmicos que podem ser providos (Adaptado de Lescourret 2015).
Como exemplo, podemos citar o trabalho de Harrison et al. (2014), que aponta relações positivas entre atributos de biodiversidade e serviços ecossistêmicos. Em um levantamento realizado por esses autores, serviços de regulação da qualidade da água, regulação de fluxos hídricos, regulação de
27 CONSERVAÇÃO DA BIODIVERSIDADE
fluxos de massa e estética da paisagem foram melhorados pelo aumento das áreas de habitats. Características funcionais, como riqueza e diversidade, também mostraram uma relação predominantemente positiva entre os serviços, com destaque para regulação atmosférica, regulação de pragas e polinização. A abundância de espécies foi particularmente importante para a regulação de pragas, polinização e recreação.
Segundo Altieri (1999), o tipo e a abundância da biodiversidade diferem entre agroecossistemas (que diferem em idade, diversidade, estrutura, gestão e manejo, e que apresentam grande variabilidade nos padrões ecológicos e agronômicos). Em geral, o grau de biodiversidade dos agroecossistemas depende de quatro características principais: (1) a diversidade da vegetação dentro e ao redor do agroecossistema; (2) a permanência das várias culturas dentro dele; (3) a intensidade do manejo e (4) o grau de isolamento entre o agroecossistema e ecossistemas naturais na paisagem.
Nesse ínterim, existem dois componentes distintos da biodiversidade nos agroecossistemas. A biodiversidade planejada (associada às plantas e animais propositalmente inseridos no agroecossistema pelo agricultor, que irá variar dependendo dos insumos, das práticas de manejo e dos arranjos espaciais e temporais das culturas), e a biodiversidade associada (que inclui as espécies que colonizam o agroecossistema a partir de ambientes circundantes, e que prosperarão - ou não - no agroecossistema, dependendo de seu manejo). A chave para o manejo – e no contexto deste texto, também para a conservação da diversidade e garantia de serviços ecossistêmicos - é identificar o tipo de biodiversidade que é desejável, manter e/ou melhorar, e depois determinar as melhores práticas que encorajarão a permanência dos componentes desejados dessa biodiversidade (Altieri 1999, Perfecto e Vandermeer 2008).
A estrutura e a composição escolhidas para os sistemas de produção, assim como o seu manejo, é que vão determinar os componentes da biodiversidade nos agroecossistemas e seu entorno. O manejo, como agente da conservação da biodiversidade, deve ser, portanto, definido considerando não somente a estrutura e a composição do agroecossistema em si, mas também a biodiversidade da paisagem vizinha (Fig 4).
A partir de todos esses pressupostos, enfatizamos aqui que a promoção da conservação da biodiversidade, no contexto agrícola, deve envolver a diversificação dentro e entre agroecossistemas, e sua integração em paisagens multifuncionais. Para Perfecto e Vandermeer (2008), deve-se pensar em manter ou construir uma matriz que seja “amigável” para a biodiversidade. Na Ecologia de Paisagens se enfatiza a importância do contexto espacial sobre os processos ecológicos, e a importância destas relações para a conservação biológica. A estrutura da paisagem (ou seja, o tipo, distribuição e conformação dos elementos que a compõem) vão torná-la mais ou menos favorável para a permanência e sustentabilidade de populações de diferentes espécies, a partir da presença – ou não – de habitats mais favoráveis para elas. Paisagens mais
28 DESENVOLVIMENTO SUSTENTÁVEL
heterogêneas têm mais chance de conter um maior conjunto de habitats favoráveis para um conjunto maior de espécies.

Figura 4. Relação entre a biodiversidade planejada (determinada pelos agricultores e baseada no manejo do agroecossistema) e a biodiversidade associada, e como as duas promovem serviços ambientais e ecossistêmicos (Adaptada de Altieri 1999).
Nos trópicos, como já vimos, uma boa parte do uso da terra é de pastagens e agricultura, com habitats naturais altamente fragmentados e embebidos por essa matriz agrícola (Perfecto e Vandermeer 2008). A matriz, nesse caso, seria o conjunto de unidades que compõem um mosaico inter-habitats (Metzger 2008), em diferentes escalas. No caso da matriz predominante ser a agricultura, as ações de conservação da biodiversidade devem estar centradas em tornar essa matriz menos inóspita para a biodiversidade associada e a biodiversidade silvestre, e permitir fluxos de espécies e propágulos dentro e entre os diferentes agroecossistemas.
Segundo Metzger (2008), as unidades da paisagem podem ser caracterizadas segundo sua permeabilidade a fluxos biológicos. Para aumentar a permeabilidade da matriz, pode-se modificar as características das unidades que a compõem, de forma que elas mais se assemelhem às características dos habitats que se quer preservar e/ou resgatar. Podemos pensar em planejar, implantar e manejar os agroecossistemas com esse propósito. Agroecossistemas mais simplificados (compostos por monocultivos ou cultivos de poucas espécies) vão sempre apresentar uma menor diversidade planejada que aqueles mais complexos (como policultivos, sistemas agroflorestais multiestratificados e outros).
Altieri (1999, 2002) argumenta que a diversificação dentro dos agroecossistemas, a partir de monocultivos, deve ser orientada por processos de
29 CONSERVAÇÃO DA BIODIVERSIDADE
transição agroecológica, e a diversificação nos sistemas de produção vai depender se os monocultivos são formados por plantas anuais ou perenes - as culturas perenes tendem a ser mais facilmente convertidas em agroecossistemas mais estáveis e com alta diversidade. Em seus textos, Altieri destaca os sistemas agroflorestais multidiversificados, que possuem maior potencial de oferecer habitat para insetos benéficos ao sistema e melhorar as condições ambientais, favorecer funções como a fixação de nitrogênio atmosférico, aumento do teor de matéria orgânica e atividade biológica no solo. Para o autor, a Agroecologia aproveita melhor os processos naturais e as interações benéficas nas propriedades, a fim de reduzir o uso de insumos e melhorar a eficiência dos sistemas agrícolas, o que tende a melhorar a biodiversidade funcional dos agroecossistemas, bem como a conservação dos recursos naturais existentes na propriedade. Essas tecnologias, como culturas de cobertura, consorciação de adubos verdes, consórcios agroflorestais e lavoura -pecuária são multifuncionais, pois sua adoção geralmente significa mudanças favoráveis em vários componentes dos sistemas agrícolas ao mesmo tempo. Essas tecnologias podem influenciar componentes do agroecossistema e seus processos, melhorar a diversidade genética no agroecossistema no tempo e no espaço e promover interações biológicas e sinérgicas benéficas entre os componentes da agrobiodiversidade. Na análise feita por Perfecto e Vandermeer (2008), os agroecossistemas podem compreender habitats para a biodiversidade (a partir de sua estrutura e composição), ou componentes que facilitem migração e fluxos biológicos na matriz onde estão inseridos – como sistemas que trazem maior permeabilidade as paisagens que ajudam a construir. Para esses autores, “A matriz dentro da qual os bons habitats estão localizados pode ter várias qualidades, em termos de sua capacidade de apoiar os serviços necessários para os mesmos. Em resumo, uma coleção de reservas biológicas em um mar de agricultura intensiva dominada por monoculturas e aplicações de pesticidas é provavelmente muito pior para a conservação geral da biodiversidade do que uma coleção menor de reservas biológicas em um mar de diversos agroecossistemas gerenciados organicamente e com alguma cobertura de árvores. A matriz é importante!”
Eles apontam estratégias, para favorecer esses processos, manejando a biodiversidade planejada e associada, a partir de vários argumentos: Nos cultivos anuais: utilizar consórcios de espécies é altamente benéfico e recomendado. Usar espécies que exploram diferentes nichos torna a utilização do ambiente e seus recursos mais eficiente. A diversificação dos sistemas anuais de cultivo, mesmo com poucas espécies, pode aumentar os taxa de biodiversidade associada presentes no sistema (como formigas, vespas e aranhas). A proteção contra pragas e doenças também é beneficiada, e a combinação de culturas encoraja inimigos naturais no sistema, o que contribui indiretamente para a conservação da biodiversidade pelo uso mais reduzido
30 DESENVOLVIMENTO SUSTENTÁVEL
de agrotóxicos. Os sistemas consorciados podem contribuir também para a subsistência dos agricultores, o que reduz a pressão sobre as florestas e outros ecossistemas nativos.
Nos cultivos perenes: A utilização de sistemas tradicionais como quintais ou hortos caseiros mistos também são citados como sistemas conservadores de biodiversidade. Além deles, sistemas perenes multiestratificados (como sistemas agroflorestais multiestrato, sistemas silvopastoris e consórcios de árvores) são uma forma de reinserir o componente arbóreo nativo de volta à paisagem, possibilitando todo um conjunto de interações, com possibilidade de atração de animais polinizadores e dispersores e de fornecer nichos para várias espécies (Oliveira e Carvalhaes 2016). SAFs com café e cacau, especialmente os mais diversificados, têm demonstrado ser matrizes de alta qualidade (ou seja, sistemas de uso do solo que facilitam a migração de organismos entre fragmentos de habitats nativos). A presença de várias árvores nativas como sombreadoras nesses sistemas são fundamentais para esse desempenho. Alguns sistemas silvipastoris também têm demonstrado ser eficientes, a presença de árvores de várias espécies facilita o fluxo de animais.
Do ponto de vista da construção de paisagens multifuncionais, a diversificação também pode se dar a partir da inserção, por exemplo, de elementos arbóreos fora dos agroecossistemas, constituindo cercas vivas ou quebra-ventos, ou mesmo formando pequenos agrupamentos em pastagens e aumentando a permeabilidade da matriz em um ambiente altamente degradado, com baixa diversidade. Nesse caso, a diversificação na paisagem contribuiria para a manutenção da biodiversidade de funções e processos ecológicos associados, e a migração de organismos importantes para essas funções (Perfecto e Vandermeer 2008).
É fundamental destacar que a estrutura e a composição dos agroecossistemas, bem como a escolha da dinâmica e estratégias de manejo devem ser determinados em um processo coletivo, em que todos os beneficiários participem das tomadas de decisão.
CONSIDERAÇõES FINAIS
O avanço do conhecimento nos campos da Ecologia e da Agroecologia tem sugerido cada vez mais a importância do papel da Agricultura na conservação da Biodiversidade. Os agroecossistemas podem, e devem ser planejados de forma que sua estrutura e manejo ofereçam ambientes amigáveis para a biodiversidade, promovendo a sua conservação, além de trazer benefícios e melhorias para as paisagens rurais. Nesse processo, destaca-se fortemente o papel da agricultura familiar e suas organizações, a importância do manejo agroecológico dos sistemas de produção - promovido em suas mais variadas escalas, e a valorização do conhecimento e modos de vida de comunidades tradicionais. Além disso, formas mais convencionais de agricultura também
31 CONSERVAÇÃO DA BIODIVERSIDADE
podem gerar ganhos na conservação da biodiversidade, a partir da valorização das biodiversidades planejada e associada, e de um manejo mais consciente, minimizando os impactos ambientais e preservando os recursos naturais.
A participação de múltiplos atores, um processo contínuo de aprendizagem e a tomada de decisão baseado em negociações transparentes, em que haja um efetivo e claro compartilhamento de benefícios e responsabilidades, devem ser as bases para um novo modelo de Desenvolvimento Rural Sustentável, em que a conservação da biodiversidade e dos serviços ecossistêmicos associados representem grandes benefícios para a sociedade.
REFERêNCIAS BIBLIOGRÁFICAS
Altieri MA (1999) The ecological role of biodiversity in agroecosystems. Agriculture, Ecosystems and Environment, 74:19-31.
Altieri MA (2002) Agroecology: the science of natural resource management for poor farmers in marginal environments. Agriculture, Ecosystems and Environment, 93:1-24.
Arnesto JJ, Bautista S, Del Val E et al. (2017) Towards an ecological restoration network: reversing land degradation in Latin America. Frontiers in Ecology and the Environment, (4):1-4.
Barral MP, Rey Benayas JM, Meli P, Maceira NO (2015) Quantifying the impacts of ecological restoration on biodiversity and ecosystem services in agroecosystems: A global meta-analysis. Agriculture, Ecosystems and Environment 202:223-231.
Boody G, De Vore D (2006) Redesigning agriculture. BioScience 56(10):839845.
Brasil. Decreto Federal no 2.519, de 16 de março de 1998. Promulga a Convenção sobre Diversidade Biológica. http://www.planalto.gov.br/ccivil_03/ decreto/D2519.html. Acesso Abril de 2019.
Brasil. Decreto Federal no 6.476 de 05 de junho de 2008. Promulga o Tratado Internacional sobre Recursos Fitogenéticos para a Alimentação e a Agricultura. http://www.planalto.gov.br/ccivil_03/_Ato2007-2010/2008/Decreto/ D6476.htm. Acesso Abril de 2019.
Buschbacher R (2014) A teoria da resiliência e os sistemas socioecológicos: como se preparar para um futuro imprevisível? Boletim Regional, Urbano e Ambiental, 9:11-24.
Carvalhaes MA, Oliveira RE (2017) Práticas agroextrativistas, dinâmica social e conhecimento científico: base para boas práticas de manejo da palmeira babaçu. In: Conservação e uso da agrobiodiversidade - Relatos de experiências locais. EMBRAPA, Brasília. pp.165-187.
Conway GR (1987) The Properties of Agroecosystems. Agricultural Systems, 24:95-117.
Dudley N, Alexander S (2017) Agriculture and biodiversity: a review. Biodiversity, 18(2-3):45-49. doi:10.1080/14888386.2017.1351892.
Dudley N, Attwood S, Goulson D, Jarvis D, Bharucha ZP, Pretty J (2017) How should conservationists respond to pesticides as a driver of biodiversity loss
32 DESENVOLVIMENTO SUSTENTÁVEL
in agroecosystems? Biological Conservation, 209:449-453. doi:10.1016/j. biocon.2017.03.012
FAO-Food and Agriculture Organization of the United Nations (2011). The state of the world’s land and water resources for food and agriculture: Managing systems at risk. http://www.fao.org/3/i1688e/i1688e.pdf. Acesso Março de 2019.
FAO-Food and Agriculture Organization of the United Nations (2019) The state of the world’s biodiversity for food and agriculture. http://www.fao.org/ state-of-biodiversity-for-food-agriculture/en/. Acesso Março de 2019.
Fé EGM, Gomes JMA (2015) Territorialidade e sociobiodiversidade na configuração do espaço produtivo da comunidade olho d’água dos negros no município de Esperantina-PI. Sociedade & Natureza, 27:297-308.
Figueiredo RA, Alcântara LCS, Morais JPG, Sais AC, Oliveira RE (2017) Resiliência em sistemas socioecológicos, paisagem rural e agricultura. Ciência, Tecnologia e Ambiente, 5(1):49-57. doi:10.4322/2359-6643.05103.
Flores JCG, Cedillo JGG, Plata MAB, Santana MRA (2016) Sociocultural and environmental benefits from family orchards in the Central Highlands of Mexico. Bois et Forêts des Tropiques, 329 (3):29-42.
Gillson L (2015 ) Biodiversity Conservation and Environmental Change: Using Palaeoecology to Manage Dynamic Landscapes in the Anthropocene. Oxford and New York: Oxford University Press, 215p.
Gliessman SR (2009). Agroecologia: Processos ecológicos em Agricultura Sustentável. UFGRS. Porto Alegre, 637p.
Harrison PA, Berry PM, Simpson G et al. (2014) Linkages between biodiversity attributes and ecosystem services: A systematic review. Ecosystem Services, 9:191-203.
Jackson L, Bawa K, Pascual U, Perrings C (2005) Agrobiodiversity: A new science agenda for biodiversity in support of sustainable agroecosystems. FAO. http://www.fao.org/fileadmin/templates/soilbiodiversity/Downloadable_files/Jackson_20et_20al_20Science_20plan_20agroBIODIVERSITY. pdf. Acesso Março de 2019.
Kazemi H, Klug H, Kamkara B (2018) New services and roles of biodiversity in modern agroecosystems: A review. Ecological Indicators, 93:1126-1135. doi:10.1016/j.ecolind.2018.06.018.
Knickel K, Redman M, Darnhofer I. et al. (2018) Between aspirations and reality: Making farming, food systems and rural areas more resilient, sustainable and equitable. Journal of Rural Studies, 59:197-210. doi:10.1016/j. jrurstud.2017.04.012.
Landis DA (2017) Designing agricultural landscapes for biodiversity-based ecosystem services. Basic and Applied Ecology, 18:1-12. doi:10.1016/j. baae.2016.07.005.
Lescourret S, Magda D, Richard G. et al. (2015) A social-ecological approach to managing multiple agro-ecosystem services. Current Opinion in Environmental Sustainability, 14:68-75. doi:10.1016/j.cosust.2015.04.001.
Mazzetto Silva CE (2009) Ordenamento Territorial no Cerrado brasileiro: da fronteira monocultora a modelos baseados na sociobiodiversidade. Desenvolvimento e Meio Ambiente, 19:89.
33 CONSERVAÇÃO DA BIODIVERSIDADE
Metzger JP (2008) Como restaurar a conectividade em paisagens fragmentadas? In: Restauração ecológica de ecossistemas naturais. FEPAF, Botucatu, pp.49-76.
O’Farrell PJ, Anderson PML (2010) Sustainable multifunctional landscapes: a review to implementation. Current Opinion in Environmental Sustainability, 2(1–2):59-65. doi:10.1016/j.cosust.2010.02.005.
Oliveira RE, Carvalhaes MA (2016) Agroforestry as a tool for restoration in atlantic forest: Can we find multi-purpose species? Oecologia Australis, 20(4):425-435. doi:10.4257/oeco.2016.2004.03.
Perfecto I, Vandermeer J (2008) Biodiversity Conservation in Tropical Agroecosystems: A New Conservation Paradigm. Annals of the New York Academy of Sciences, 1134: 173-200. doi:10.1196/annals.1439.01.
Petersen P, Silveira LM, Fernandes GB, Almeida SG (2017) Método de Análise Econômico-Ecológica de Agroecossistemas. AS-PTA. http://aspta.org.br/ wp-content/uploads/2017/03/2-livro.pdf. Acesso Março de 2019.
Resilience Alliance (2010) Assessing resilience in social-ecological systems: workbook for practitioners. Version 2.0. https:// www.resalliance.org/files/ ResilienceAssessmentV2_2.pdf. Acesso Março de 2017.
Santilli J (2012) O acesso aos recursos fitogenéticos para alimentação e agricultura: regime jurídico internacional e nacional. In: Agrobiodiversidade no Brasil – experiências e caminhos de pesquisa. NUPEEA. pp.13-52.
Santos ALS, Pereira ECG, Andrade LHC A construção da paisagem através do manejo de recursos naturais e a valorização do etnoconhecimento. In: Povos e Paisagens: Etnobiologia, Etnoecologia e Biodiversidade no Brasil. NUPEEA. pp.61-73.
Sayer J, Sunderland T, Ghazoulc J. et al. (2013) Ten principles for a landscape approach to reconciling agriculture, conservation, and other competing land uses. Proceedings of the national academy of sciences, 110(21):8349-8356.
Semeghini M, Andrade CDG, Kurihara L, Menezes M (2017) Experiências regionais para conservação da agrobiodiversidade na região Norte do Brasil O caso do Baixo Rio Negro. In: Conservação e uso da agrobiodiversidadeRelatos de experiências locais. EMBRAPA, Brasília. pp.97-128.
Zimmerer KS (2004) Conserving agrobiodiversity amid global change, migration, and nontraditional livelihood networks: the dynamic uses of cultural landscape knowledge. Ecology and Society, 19(2):1-15. doi:10.5751/ES06316-190201.
34 DESENVOLVIMENTO SUSTENTÁVEL
3
FERTILIDADE DO SOLO E NUTRIÇÃO NA PRODUÇÃO
E SANIDADE DE PLANTAS
Cledimar R. Lourenzi1, Jucinei J. Comim1, Arcângelo Loss1 , Paulo A. A. Ferreira2 , Monique Souza1 , Lucas Benedet3 , Guilherme W. Ferreira1 , Lucas D. Giumbelli1
1 Universidade Federal de Santa Catarina (UFSC), Centro de Ciências Agrárias, Departamento de Engenharia Rural, Programa de Pós-Graduação em Agroecossistemas, Rod. Admar Gonzaga, 1346, 88034-001, Florianópolis-SC, Brasil. E-mail: lourenzi.c.r@ufsc.br
2 Universidade Federal de Santa Maria (UFSM), Coordenadoria Acadêmica, Campus Cachoeira do Sul, Rua Ernesto Barros, 1345, Bairro Santo Antônio, 96506-322, Cachoeira do Sul-RS, Brasil. E-mail: paulo.ferreira@ufsm.br
3 Universidade Federal de Lavras (UFLA), Departamento de Ciência do Solo, Programa de PósGraduação em Ciência do Solo, 37200-000, Lavras-MG, Brasil. E-mail: lucas_benedet@hotmail. com
INTRODUÇÃO
A busca por alimentos mais “saudáveis” tem ganhado destaque entre os consumidores nos últimos anos, especialmente em relação aos alimentos produzidos sem uso de defensivos agrícolas, como herbicidas, inseticidas e fungicidas. Para atender a essa demanda e também aumentar a oferta de produtos de melhor qualidade ao consumidor, é necessário a adoção de práticas que tornem a agricultura mais sustentável. Dentre essas práticas podese destacar o uso racional das fontes de nutrientes (minerais e/ou orgânicas), maximizando a absorção pelas plantas e diminuindo os custos de produção; o manejo do solo sem revolvimento, o que mantém os teores de matéria orgânica e favorece a atividade microbiana; o uso de plantas de cobertura, mantendo o solo coberto; rotação de culturas, que pode auxiliar no combate a pragas e doenças ao longo do tempo, entre outras.
Para elucidar um pouco sobre algumas das práticas citadas anteriormente, o presente capítulo irá abordar aspectos relacionados a fertilidade do solo que apresentam extrema importância no que tange a adoção e a prática de uma agricultura mais sustentável. Para se alcançar esse patamar, um dos primeiros passos é “cuidar do solo”, especialmente da sua capacidade de armazenar e fornecer nutrientes às plantas na quantidade e no tempo certo, nutrindo-as adequadamente, o que é sinônimo de planta saudável.
Nesse sentido, ir-se-á abordar os seguintes aspectos: acidez do solo, salientando a importância de se manter o solo em faixas de pH adequadas e enfatizando os principais efeitos negativos provocados pela acidez; disponibiStadnik MJ, Velho AC, Zorrilla SE (eds.) Desenvolvimento Sustentável na Produção Agroalimentar
35
lidade e absorção de nutrientes essenciais, enfatizando as principais formas absorvidas, funções na planta e os principais sintomas de deficiência e toxidez de cada elemento; relações entre nutrição mineral, fertilidade do solo e adubação, enfatizando como a fertilidade do solo e a prática da adubação podem afetar a nutrição das plantas; relação entre produtividade, nutrição e sanidade das plantas, buscando destacar aspectos relacionados a nutrição das plantas que promovam a sanidade mas que ao mesmo tempo proporcionem boas produtividades e, consequentemente, a sobrevivência financeira dos produtores. Dessa forma, buscamos apresentar ao leitor uma abordagem que apresente os principais aspectos da fertilidade do solo a serem considerados para uma agricultura mais sustentável.
1. ACIDEZ E CORREÇÃO DO SOLO
A acidez é um dos principais parâmetros químicos do solo limitantes a produção agrícola em regiões tropicais e subtropicais. O processo de acidificação é algo que ocorre naturalmente, influenciado principalmente pela dissolução parcial do gás carbônico (CO2) atmosférico na água da chuva, que resulta em hidrogênios (H+) livres para reagir com os coloides e permanecer na solução do solo, acidificando o meio. Além disso, a decomposição da matéria orgânica, a hidrólise do alumínio trocável (Al3+) e a atividade antrópica, como a aplicação de adubos altamente solúveis, especialmente fontes amoniacais de nitrogênio, são fatores que conduzem à acidificação, afetando a dinâmica dos nutrientes e também a presença de elementos tóxicos, como o Al3+ . A acidez do solo é dividida em acidez ativa, que consiste nos íons H+ na solução do solo, estimada pelo pH (pH em H2O ou em soluções salinas, como o KCl e CaCl2), e acidez potencial, que representa a capacidade do solo em resistir as variações do pH (poder tampão) e está relacionada aos íons H+ e Al3+ adsorvidos às cargas negativas dos coloides e que se encontram em equilíbrio com a solução do solo, estimada por soluções tamponantes, como a solução SMP (CQFS-RS/SC 2016), que é uma medida indireta dos teores de H+Al no solo.
Devido à localização geográfica em que o Brasil se encontra, com predomínio de clima tropical e subtropical, a maioria dos solos formados sofreram forte influência do intemperismo químico, resultando principalmente na lixiviação de bases como potássio (K+), cálcio (Ca2+) e magnésio (Mg2+), e favorecendo a permanência em maiores concentrações dos íons Al3+ e H+ , originando solos naturalmente ácidos.
Estes dois elementos podem interferir de duas formas no crescimento de plantas: 1) diminuindo a absorção de nutrientes devido a alteração na dinâmica de adsorção dos elementos aos coloides, ou alteração das formas dos elementos em solução em função da variação do pH do solo; 2) redução do crescimento e/ou desenvolvimento radicular devido a absorção de Al3+ pelas plantas. Esses efeitos interferem no potencial produtivo das culturas sendo,
36 DESENVOLVIMENTO SUSTENTÁVEL
portanto, importante a manutenção e/ou correção do pH nos solos para valores adequados ao desenvolvimento das culturas. A figura 1 apresenta o efeito do pH na disponibilidade dos nutrientes no solo.

Figura 1. Disponibilidade dos nutrientes em relação ao pH da solução do solo (Fonte: Malavolta 1979).
Um dos principais efeitos da acidificação do solo é o aumento da disponibilidade de Al3+ , que pode causar toxidez às plantas. Em solos com pH < 5,5 há aumento do Al3+ e, consequentemente, seus efeitos nocivos às plantas. Além disso, o Al3+ em solução pode sofrer o processo de hidrólise, a qual constitui uma importante fonte de H+ no solo, ou seja, é geradora de acidez (Faquin 2005). No entanto, quando o solo apresenta pH >5,5, o Al3+ é neutralizado (precipitado), formando hidróxidos, e seus efeitos nocivos às plantas não são mais observados na maioria das culturas.
Além do Al3+, a acidificação do solo também aumenta a disponibilidade de Mn2+ que, apesar de ser um micronutriente necessário ao desenvolvimento das plantas, quando em elevadas concentrações pode causar toxidez e prejudicar o desenvolvimento das mesmas. No entanto, diferente do Al3+ que é totalmente precipitado, a elevação dos valores de pH para faixas entre 5,5 e 6,0 apenas diminui a sua disponibilidade, mantendo concentrações adequadas ao desenvolvimento das plantas. Outro efeito importante da acidificação do solo está relacionado à disponibilidade de P que, devido ao aumento das cargas positivas pH dependentes nos coloides do solo, fica adsorvido fortemente em solos com maior nível de acidez, especialmente as formas H2PO4- e HPO4 2, principais formas absor-
37 Fertilidade do solo e nutrição de plantas
vidas pelas plantas. Dessa forma, há redução nos teores disponíveis de P e as plantas podem não absorver as quantidades necessárias para o seu desenvolvimento, afetando a produtividade e a qualidade dos produtos gerados.
Para corrigir a acidez do solo e, consequentemente, elevar os valores de pH do solo, realiza-se a calagem, que consiste na aplicação de corretivos, como o calcário, o qual é obtido a partir da moagem de rochas calcárias. Os principais constituintes do calcário são o carbonato de cálcio (CaCO3) e o carbonato de magnésio (MgCO3). No solo, após a aplicação e a solubilização, a reação do calcário libera Ca2+ e Mg2+, nutrientes essenciais, além de hidroxilas (OH-) e íons bicarbonatos (HCO3 -) que serão os responsáveis por neutralizar os íons H+ e Al3+, conforme equações abaixo, elevando os valores de pH do solo.
H+ + OH- ↔ H2O Equação 1 – Neutralização do H+ em solução
Al3+ + 3OH- ↔ Al(OH)3 Equação 2 – Neutralização do Al3+ em solução
H+ + HCO3- ↔ H2 CO3 Equação 3 – Formação do ácido carbônico
HCO3 - ↔ H2O + CO2- Equação 4 – Decomposição do ácido carbônico
Além do calcário, podem ser utilizados outros produtos para a correção da acidez do solo, como por exemplo: cal virgem, cal hidratada, calcário calcinado, carbonato de cálcio, entre outros. Independente do produto a ser utilizado, é importante destacar que a manutenção dos valores de pH em faixas adequadas ao desenvolvimento das culturas, normalmente entre 5,5 e 6,0 (CQFS-RS/SC 2016), irá proporcionar condições ao solo para manter adequada disponibilidade de nutrientes, além de evitar problemas de toxidez causados pela presença do Al3+, possibilitando maximizar a produtividade, promover maior sanidade das plantas e gerar produtos de melhor qualidade.
2. DISPONIBILIDADE E ABSORÇÃO DE NUTRIENTES ESSENCIAIS
As quantidades de nutrientes exigidas pelas plantas ocorrem em função dos seus teores no material vegetal e do total de matéria seca produzida. Sob o ponto de vista da nutrição mineral, os nutrientes essenciais são classificados como macro e micronutrientes. Os macronutrientes (N, P, K, Ca, Mg e S) são exigidos em maiores quantidades, equivalentes a kg ha-1, enquanto que os micronutrientes (B, Cl, Cu, Fe, Mn, Mo, Ni e Zn) são exigidos em quantidades equivalentes a g ha-1 .
2.1 Macronutrientes
A seguir os macronutrientes serão descritos de acordo com sua disponibilidade na superfície terrestre, disponibilidade nos solos, formas de absorção e funções na planta, bem como sintomas de deficiência e/ou excesso.
38 DESENVOLVIMENTO SUSTENTÁVEL
Nitrogênio (N) - O N é considerado o elemento mais abundante da atmosfera terrestre, a qual possui aproximadamente 78% de N2 (Dechen e Nachtigall 2007). É essencial para as plantas, pois está presente na composição das mais importantes biomoléculas (Harper 1994). O N2 atmosférico, para ser absorvido pelas plantas, necessita passar por transformações para as formas combinadas NH4 + e NO3- (formas minerais absorvidas pelas plantas), sendo os principais processos responsáveis pela fixação do N2 atmosférico a fixação biológica de N, fixação industrial e fixação atmosférica. Cerca de 90% do N presente nas plantas encontra-se em forma orgânica, e como componente estrutural de macromoléculas e constituinte de enzimas. O N participa do metabolismo das plantas na formação de aminoácidos e proteínas, além de clorofila e citocromos, DNA e RNA, coenzimas como o NAD (nicotinamida adenina dinucleotídeo) e o NADP (nicotinamida adenina dinucleótido fosfato). A baixa absorção de N pelas plantas reflete em menor desenvolvimento, além das plantas apresentarem coloração verde-clara, caracterizada por uma clorose generalizada, principalmente nas folhas mais velhas (Furlani 2004). Por outro lado, o excesso de N provoca crescimento excessivo da parte aérea, além de reduzir a qualidade dos produtos formados (Dechen e Nachtigall 2007).
Fósforo (P) - O fósforo é o décimo segundo elemento químico mais abundante na crosta terrestre (Schulze 1989), mas nos solos tropicais é o segundo elemento que mais limita a produtividade. Além da carência generalizada de P nos solos brasileiros, o elemento apresenta forte interação com o solo (fixação), o que reduz a eficiência da adubação fosfatada. O P é um dos macronutrientes exigido em menores quantidades pelas plantas, mas se trata do elemento mais usado nos sistemas de recomendação de adubação. As plantas absorvem a maior parte do P como íon ortofosfato primário (H2PO4-), porém pequenas quantidades de íon ortofosfato secundário (HPO42-) são também absorvidas. O pH do solo influencia a relação de absorção desses dois íons pelas plantas. O H2PO4- tem sua disponibilidade aumentada em valores de pH abaixo de 7,0, enquanto o HPO4 2- em valores de pH acima de 7,0 (Dechen e Nachtigall 2007). O P requerido para o ótimo crescimento das plantas varia, dependendo da espécie e do órgão analisado, de 0,1 a 0,5% na matéria seca. O P tem função importante na fotossíntese, respiração, armazenamento e transferência de energia, divisão de células, crescimento das células e vários outros processos nas plantas. É um elemento muito móvel nas plantas e sua translocação se dá dos tecidos mais velhos para os mais novos, de modo que quando há sintomas de deficiência, ocorrem principalmente nas partes mais baixas da planta. O primeiro sintoma de deficiência é a redução do crescimento, seguido por folhas retorcidas. Em condições mais severas de deficiência, ocorrem áreas necróticas nos tecidos vegetais. As folhas apresentam coloração avermelhada, podendo ocorrer também retardo na maturação dos frutos (Dechen e Nachtigall 2007). Quando em excesso, pode ocorrer manchas vermelho-escuras nas folhas mais velhas das plantas (Malavolta 2006).
39 Fertilidade do solo e nutrição de plantas
Potássio (K) - O K é o sétimo elemento mais abundante na crosta terrestre (Skiner 1996) e é encontrado no solo em minerais primários e intemperizados, bem como nas formas trocável, não-trocável e solúvel em água (Dechen e Nachtigall 2007). O K é considerado o mais móvel dos nutrientes no sistema solo-planta-atmosfera, especialmente na planta (Malavolta 2005), sendo absorvido da solução do solo na forma iônica K+ . Entretanto, a forma e a disponibilidade do K no solo dependem, principalmente, dos minerais primários e secundários presentes no solo (Werle et al. 2008). O K não faz parte de compostos orgânicos nas plantas. Portanto, não desempenha função estrutural, mas é o íon mais abundante no citoplasma desempenhando papel fundamental na estabilização do pH neste compartimento, mantendo valores de pH entre 7 a 8, ótimo para as reações enzimáticas. Além disso, o K contribui para a regulação osmótica da planta, atua na ativação enzimática e no processo de absorção iônica. Plantas deficientes em K têm seu crescimento retardado e a redistribuição desse elemento é estimulada das folhas mais velhas para as folhas jovens (Furlani 2004), sendo a necrose das margens das folhas um dos sintomas mais comuns de deficiência de K. As plantas com deficiência em K crescem lentamente, apresentando sistema radicular mal desenvolvido, colmos frágeis, sendo comum o acamamento. Além disso, as sementes e frutos são mal desenvolvidos e as plantas podem apresentar baixa resistência a pragas e doenças (Dechen e Nachtigall 2007).
Cálcio (Ca) - O cálcio constitui 3,6 % da crosta terrestre (quinto elemento em abundância), sendo encontrado na calcita, gesso, conchas de ostras e corais, entre outros. A forma iônica de Ca2+, presente na solução do solo, é absorvida pelas plantas (Dechen e Nachtigall 2007). Ao contrário dos outros macronutrientes, uma alta proporção do Ca nas plantas encontra-se nas paredes celulares, aumentando a sua resistência. Além disso, é constituinte ou ativador de várias enzimas como alfa amilase e nucleases, sendo também requerido para a alongação e divisão celular. Plantas deficientes em Ca apresentam redução do crescimento radicular, adquirindo uma coloração escura, e acabam morrendo. Por ser um constituinte da parede celular e não ser retranslocado na planta, a sua deficiência acarreta em plantas que apresentam as nervuras das folhas novas e os pontos de crescimento de forma gelatinosa. Quando em excesso, o Ca é acumulado no vacúolo das células, não apresentando sintomas nos tecidos vegetais (Dechen e Nachtigall 2007).
Magnésio (Mg) - O Mg é o oitavo elemento mais abundante da crosta terrestre, essencial para metabolismo de plantas e animais, sendo absorvido pelas plantas, principalmente, na forma iônica Mg+2 (Dechen e Nachtigall 2007). A função mais conhecida do Mg é a de compor a molécula da clorofila, correspondendo a 2,7% do peso das mesmas e representando cerca de 15 a 20% do Mg total das folhas das plantas, além de ser importante na ativação enzimática. O Mg é bastante móvel no sistema planta, de modo que seu transporte e redistribuição ocorrem na forma iônica (Furlani 2004). A deficiência
40 DESENVOLVIMENTO SUSTENTÁVEL
de Mg é caracterizada por uma diminuição no porte, clorose internerval nas folhas mais velhas, que pode evoluir para tons mais roxos e, posteriormente, para necrose (Ferreira 2012). Ainda, pode ocorrer redução do tamanho dos frutos, assim como diminuição da acidez total e do teor de vitamina C. Não há relatos sobre a toxidez de Mg em plantas (Dechen e Nachtigall 2007).
Enxofre (S) - Estima-se que o S seja o décimo elemento mais abundante do planeta, sendo encontrado na forma elementar em depósitos de origem vulcânica, bacias de evaporitos e domos salinos; na forma de compostos ocorre nos sulfatos e sulfetos (Stipp e Casarin 2006). A produção de alimentos depende da ciclagem do S no sistema solo-planta, sendo que as interações e fluxos de S neste sistema são complexos, assim como suas interações com os demais reservatórios. As três principais fontes naturais de S para as plantas são: matéria orgânica, minerais do solo e gases de S na atmosfera (Rocha et al. 2015). Mais de 90% do S da camada superficial do solo encontra-se na forma orgânica, e a transformação do S-orgânico para formas minerais se dá pelo processo de mineralização. Embora as plantas sejam aptas a absorverem o S via foliar, obtêm a maior parte desse elemento via radicular, pela absorção da forma de SO4 2- na solução do solo. O enxofre na planta encontra-se, na sua maior parte, nas proteínas e os teores nas plantas são da ordem de 0,2 a 0,5% da matéria seca. As necessidades da maioria das culturas estão na faixa de 10 a 30 kg/ha de S, podendo ser mais elevadas para culturas exigentes.
2.2 Micronutrientes
Os micronutrientes são os elementos presentes em baixas concentrações nos tecidos vegetais ou que demandam menor necessidade às plantas para desempenhar suas funções. No entanto, os micronutrientes são tão importantes para o crescimento e desenvolvimento das plantas quanto os macronutrientes (Alfaia e Uguen 2013). Os micronutrientes são essenciais para as funções fisiológicas e bioquímicas nas plantas (Hänsch e Mendel 2009), sendo que abaixo serão apresentadas as principais formas absorvidas, as principais funções nas plantas e os sintomas de deficiência e/ou toxidez.
Boro (B) – O B é absorvido pelas raízes na forma de H3BO3 (ácido bórico, também representado como B(OH)3. O B é importante na síntese e estrutura da parede celular, sendo que mais de 90% do B nas plantas se encontra nessa estrutura (Hänsch e Mendel 2009). Este elemento é móvel no xilema, mas imóvel nas folhas. Por isso, em situações de deficiência, há baixas concentrações de B nas folhas mais novas (Wimmer et al. 2015). Essa deficiência pode reduzir o rendimento e/ou a qualidade das culturas. Os efeitos da deficiência são diversos entre as culturas, afetando o alongamento radicular, translocação de açúcar, metabolismo de carboidratos, síntese de ácidos nucléicos, potencial de membrana e metabolismo de nitrogênio, entre outros. Os efeitos de toxidez por B são mais comuns em regiões áridas, com baixa pluviosidade e má drenagem, acumulando esse elemento em níveis tóxicos. A toxidez por B altera
41 Fertilidade do solo e nutrição de plantas
o metabolismo, reduz a divisão celular da raiz e os teores de clorofila foliar e diminui os níveis de lignina e suberina, entre outros. Plantas expostas a altos níveis de B apresentam um crescimento reduzido da parte aérea e das raízes. A presença de clorose ou necrose marginal é mais típica em folhas mais velhas (Camacho-Cristóbal et al. 2008).
Cloro (Cl) – A absorção de cloreto (Cl-) é realizada conjuntamente com a absorção da água, sendo este ânion importante para a manutenção do balanço de cargas na planta, a partir da absorção de cátions e ânions (Kopsell e Kopsell 2015). O Cl existe em mais de 130 compostos orgânicos em plantas, sendo componente estrutural do fotossistema II, além de participar da regulação dos estômatos (Hänsch e Mendel 2009). Solos altamente lixiviados podem apresentar baixos teores de Cl. A deficiência de Cl pode causar o murchamento das folhas, especialmente nas margens. Em casos de deficiência severa ocorre o enrolamento das folhas mais jovens, seguido por murchamento e necrose. A divisão e a extensão celular são prejudicadas nas folhas e raízes de plantas deficientes em Cl. Isso está associado ao inchaço subapical das raízes e à formação de raízes laterais curtas, o que lhe dá uma aparência rechonchuda (Chen et al. 2010). Os sintomas típicos de toxidez por Cl são o enrolamento e queima das margens das folhas, bem como, necrose e queda das mesmas. Em geral, folhas mais velhas exibem os primeiros sintomas (Kopsell e Kopsell 2015).
Cobre (Cu) – É absorvido como Cu2+ de forma ativa, entrando no citosol das células superficiais das raízes por transportadores da família COPT (Burkhead et al. 2009). O Cu apresenta baixa mobilidade na planta, sendo retido nas raízes através da ligação com grupos carbonílicos, carboxílicos, fenólicos e sulfidrilos presentes na parede celular (Yruela 2015). O seu transporte no xilema e floema é realizado a partir de ligações com transportadores, como HMA5 (tipo-P ATPase), nicotianaminas e chaperonas (Burkhead et al. 2009), sendo encontrado principalmente nos cloroplastos, participando das reações fotossintéticas. Além disso, o Cu é essencial na respiração mitocondrial, no metabolismo de C e N e na proteção de estresses oxidativos, sendo cofator de enzimas como a superóxido dismutase (SOD) (Hänsch e Mendel 2009). Como o Cu não é eficientemente redistribuído das folhas mais velhas para folhas novas e meristemas, os sintomas de deficiência são mais perceptíveis nos tecidos novos. A deficiência de Cu causa a diminuição da taxa de crescimento, distorção ou clorose das folhas jovens, ondulação das margens das folhas, danos no meristema apical, diminuição na formação de frutos, afeta o desenvolvimento e viabilidade do pólen e prejudica o desenvolvimento do embrião e a viabilidade de sementes. Quando absorvido em altas concentrações, o Cu pode causar efeitos tóxicos, diminuindo o crescimento das raízes, devido ao seu acúmulo preferencial nesse órgão. A clorose é o sintoma mais comum de toxicidade no tecido vegetativo, mas a redução na absorção de Fe e alterações na membrana tilacóide no cloroplasto, especialmente no fotossistema II (PSII), também são efeitos marcantes (Burkhead et al. 2009).
42 DESENVOLVIMENTO SUSTENTÁVEL
Ferro (Fe) - O transporte do Fe até as raízes é determinado pela sua difusão na solução do solo, sendo sua absorção (Fe3+ e Fe2+) dependente do crescimento e densidade das raízes (Barker e Stratton 2015). Um mecanismo importante na absorção de Fe é a liberação de sideróforos pelas plantas, micorrizas e bactérias, que são capazes de formar quelatos com o Fe a partir de minerais de ferro relativamente insolúveis. Quando o complexo sideróforo-Fe retorna a superfície das raízes interage com os receptores e libera o Fe para o interior da planta (Harrington et al. 2015). No entanto, pode ocorrer competição na absorção entre Fe, Cu, Zn e Mn, causando efeitos de deficiência (Barker e Stratton 2015). Nas células, mais de 80% do Fe é encontrado nos cloroplastos, estando relacionado com sua principal função na planta: a fotossíntese. O Fe também atua na respiração mitocondrial, assimilação de N, biossíntese de hormônios (etileno, ácido giberélico, ácido jasmônico) e defesa de patógenos (Hänsch e Mendel 2009). O transporte do Fe no interior das plantas ocorre pela formação de quelatos com transportadores, principalmente com citrato (xilema) e nicotianamina e proteínas transportadoras de ferro (ITP) (floema) (Kim e Guerinot 2007, Jeong e Guerinot 2009). Sua deficiência pode causar mudanças drásticas no metabolismo do carbono, repressão de enzimas fotossintéticas e afetar enzimas envolvidas na glicólise, no ciclo do ácido cítrico e na via oxidativa das pentoses-fosfato (Connolly e Guerinot 2002). A clorose de folhas jovens é geralmente o primeiro sintoma de deficiência (Rout e Sahoo 2015). A toxidez por Fe é mais comum em solos alagados, com ambiente reduzido. Assim, esses efeitos são mais percebidos na cultura do arroz. O excesso de Fe pode causar a formação de espécies reativas de oxigênio capazes de danificar constituintes celulares pela peroxidação lipídica. Redução do tamanho e da coloração verde das folhas (principalmente as mais jovens), e manchas necróticas nas folhas, além de nanismo, falta de ramificação e escurecimento das raízes são sintomas de plantas expostas a níveis elevados de Fe. Além disso, altas concentrações de Fe reduzem a absorção de Mn, P, K, Ca e Mg (Rout e Sahoo 2015).
Manganês (Mn) – É absorvido pelas plantas na forma de Mn2+ em um sistema bifásico. Uma fase rápida acontece pelo apoplasto das células das raízes, sendo uma via não metabólica. A outra fase, mais lenta, ocorre pelo simplasto e é dependente do metabolismo vegetal. Na planta, o Mn apresenta maior mobilidade no xilema que no floema (Millaleo et al. 2010). O Mn participa ativamente no metabolismo celular, com ênfase na atividade catalítica das enzimas (Hänsch e Mendel 2009). A deficiência de Mn diminui a capacidade fotossintética foliar, devido à redução do número de unidades do fotossistema II (PSII). Solos ácidos aumentam a disponibilidade de Mn, o que pode modificar a atividade enzimática, a absorção, translocação e utilização de outros elementos (Ca, Mg, Fe e P) e causar estresse oxidativo, afetando os tilacóides e desorganizando as lamelas dos cloroplastos. Os sintomas mais comuns de níveis tóxicos de Mn são diminuição na taxa de crescimento, clorose (interveolar e marginal) e manchas necróticas nas folhas (Millaleo et al. 2010).
43 Fertilidade do solo e nutrição de plantas
Molibdênio (Mo) – O Mo é absorvido como MoO4 2, sendo sua absorção controlada metabolicamente. No entanto, sua absorção pode diminuir devido à competição com SO42-. Na planta, o MoO42- possui alta mobilidade no xilema e floema (Kopsell et al. 2015). O Mo é componente de inúmeras proteínas que participam da assimilação de N (como nitrato redutase e nitrogenase), metabolismo de S e biossíntese de fito-hormônios (Hänsch e Mendel 2009). A deficiência por Mo ocorre principalmente em solos ácidos ou com turfas, onde a sua disponibilidade é baixa, sendo os sintomas observados em toda a planta, devido a sua alta mobilidade na planta, e parecidos com aqueles causados por deficiência de N. As plantas se tornam cloróticas, têm crescimento atrofiado e restrição na quantidade de nódulos radiculares. Além disso, as folhas podem ter uma redução drástica no tamanho e irregularidades na formação, chegando à formação de necrose marginal e interveolar com extrema deficiência de Mo. Em níveis tóxicos, o Mo pode provocar má formação das folhas, descoloração (amarelo-dourada) dos tecidos da parte aérea e inibição do crescimento da raiz e parte aérea. Esses sintomas podem estar relacionados também à inibição do metabolismo do ferro pelo Mo (Kopsell et al. 2015).
Níquel (Ni) – A absorção de Ni é realizada via difusão passiva e transporte ativo. A absorção de Ni2+ pode ser inibida por Fe3+, Co2+, Ca2+, Mg2+ , NH4 + , K+ e Na+ (Yusuf et al. 2011). O Ni é componente de inúmeras enzimas (cofator) e está relacionado com a atividade da enzima urease que hidrolisa ureia em CO2 e NH3 (Hänsch e Mendel 2009). Este elemento pode ser acumulado nas raízes, mas apresenta alta mobilidade no xilema e floema. Os ácidos orgânicos (citrato e malato) e aminoácidos (histidina) são relatados como os principais responsáveis pelo transporte de Ni pelo xilema. A deficiência de Ni pode reduzir a viabilidade de sementes, pelo impedimento do crescimento embrionário, afeta o metabolismo do nitrogênio e leva ao acúmulo de níveis tóxicos de ureia no tecido e redução da atividade de nódulos em leguminosas. Em altas concentrações, o Ni causa inibição da mitose e do crescimento das plantas, de atividades enzimáticas e do metabolismo de nitrogênio, interfere na absorção de outros íons metálicos essenciais e induz estresse oxidativo. Esses efeitos modificam os processos fisiológicos da planta, resultando na redução da produção e qualidade dos frutos (Yusuf et al. 2011). Além disso, o excesso de Ni altera o balanço hídrico pela redução da absorção de H2O (Nagajyoti et al. 2010).
Zinco (Zn) – É absorvido na forma divalente (Zn2+). A presença de fosfato no solo pode afetar consideravelmente a absorção de Zn. O Zn pode se mover como um cátion divalente livre ou estar ligado a ácidos orgânicos durante o transporte de longa distância no xilema. As concentrações de zinco são bastante altas no floema, onde é provavelmente complexado com compostos orgânicos de baixo peso molecular (Barker e Eaton 2015). O Zn é importante para a produção de clorofila e carboidratos, sendo cofator de inúmeras enzimas, com destaque para a síntese e manutenção do DNA e RNA. É estimado que ±1200 proteínas contenham Zn em sua estrutura (Hänsch e Mendel 2009,
44 DESENVOLVIMENTO SUSTENTÁVEL
Alfaia e Uguen 2013). Plantas com deficiência de Zn apresentam uma redução na síntese de proteínas, redução no desenvolvimento radicular, o que afeta a absorção de água e nutrientes e reduz o crescimento e a produtividade. A floração e frutificação são muito afetadas em condições de severa deficiência de Zn. Os sintomas mais comuns de deficiência são crescimento atrofiado, entrenós e pecíolos encurtados e pequenas folhas mal formadas que resultam no sintoma de “roseta” nos estágios iniciais de crescimento de dicotiledôneas e hastes em forma de leque em monocotiledôneas (Hafeez et al. 2013). Em níveis tóxicos, o Zn reduz o crescimento e desenvolvimento, causa danos oxidativos, afeta a fotossíntese e inibe muitas funções metabólicas. A toxicidade do Zn limita o crescimento da raiz e causa clorose nas folhas mais jovens. Outro efeito típico da toxidez do Zn é o aparecimento de uma cor vermelho-arroxeada nas folhas, que é atribuída à deficiência de P (Nagajyoti et al. 2010).
3. RELAÇõES ENTRE NUTRIÇÃO, FERTILIDADE DO SOLO E ADUBAÇÃO
O estudo da interação solo-planta envolve o conhecimento de processos físicos, químicos e biológicos, os quais estão interligados e são dependentes direta ou indiretamente. Para que as culturas de interesse econômico expressem boa produção faz-se necessário que os nutrientes estejam disponíveis na solução do solo e em quantidades adequadas às plantas. A adubação, seja ela orgânica ou mineral, pode ser definida como a adição de nutrientes necessários ao desenvolvimento e produção de grãos ou fitomassa, por exemplo.
A fertilidade é a capacidade que o solo tem de fornecer nutrientes para as plantas. Ela é avaliada por meio da amostragem do solo, que após seco e peneirado é submetido à análise com extratores químicos específicos, dependendo do nutriente. Esses extratores tentam simular as raízes, obtendo a quantidade total de nutrientes que uma planta poderia absorver. Na nutrição, as próprias raízes são os extratores de nutrientes do solo, e para saber o que a mesma absorveu, são analisadas as partes aérea e, em alguns casos, raízes. As plantas são excelentes indicadoras do estado da fertilidade do solo. Se a disponibilidade de nutrientes essenciais para o desenvolvimento da cultura estiver baixa e/ou há presença de elementos tóxicos, as plantas expressam sintomas visíveis que demonstram essas condições no solo. Portanto, está na fertilidade do solo a base para uma adequada nutrição das plantas. Não se pode ter uma planta bem nutrida se a mesma estiver se desenvolvendo em um solo com baixa fertilidade. Porém, pode-se ter uma planta com deficiência de nutrientes sendo cultivada em solo fértil, o que pode ser devido aos seguintes fatores: a) presença de elementos tóxico no solo; b) problemas de compactação do solo; c) pragas ou doenças que afetam o desenvolvimento radicular; d) falta de água para que se tenha a adequada absorção dos nutrientes.
A difusão dos conhecimentos adquiridos sobre as relações entre fertilidade do solo, nutrição mineral e adubação, visando o adequado desenvolvi-
45 Fertilidade do solo
nutrição de plantas
e
mento da cultura de interesse econômico, deve ser feito mediante as seguintes questões, conforme relatado por Malavolta (1979):
Determinação dos elementos limitantes: por meio de sintomas de carência, anormalidades visíveis e específicas do elemento em falta no solo; análise do solo por meio da avaliação quantitativa do elemento em falta; diagnose foliar por meio da composição da folha, visando indicar o elemento que falta no solo; ensaios de adubação através da identificação do elemento faltante em função da resposta diferencial da planta à aplicação de adubos.
Estabelecimento das quantidades necessárias: exigências quantitativas através da análise mineral da planta para verificar as quantidades dos elementos exigidos; análise do solo para calibrar com os ensaios de adubação e determinar as quantidades a aplicar.
Época de aplicação: análise periódica da planta para a determinação dos períodos de maior exigência; ensaios de adubação para o fornecimento dos elementos em épocas diversas, seguido de observação do seu efeito na produção e na composição da planta.
Localização: determinação da distribuição das raízes absorventes por observação direta ou por medida da absorção do elemento colocado em diferentes posições no solo; comportamento do elemento no solo por mecanismos que determinam o contato entre o elemento e a raiz; ensaios de adubação para determinar a absorção do elemento colocado em posições diferentes em relação à semente ou à planta, medida pela colheita ou análise da cultura.
Rentabilidade: análises da relação entre preço de adubo e lucro obtido por meio de dados de ensaios de doses crescentes do elemento.
Efeito na qualidade do produto colhido: análises químicas ou sensoriais para verificar alterações provocadas pelo adubo na composição do produto ou na sua aceitação pelo consumidor.
Efeito na qualidade do ambiente: observações e análises de solo, água e ar visando as alterações nos teores de constituintes normais, aparecimento de produtos estranhos; seu efeito no homem e no animal. Pelo exposto acima, verifica-se que há uma relação interdisciplinar entre nutrição de plantas e fertilidade do solo. Por isso, o conhecimento sobre fertilidade do solo, adubação e nutrição de plantas é essencial para que o produtor possa produzir adequadamente e aumentar a sua produtividade.
4. RELAÇÃO ENTRE PRODUTIVIDADE, NUTRIÇÃO E SANIDADE DAS PLANTAS
Apesar das plantas não possuírem sistema imunológico como os animais, elas apresentam uma série de mecanismos de defesa. Todo o metabolismo vegetal está condicionado aos processos fotossintéticos e, destes, por sua vez, resultam substâncias as quais irão originar os metabólitos secundários, que desempenham diversas funções ecológicas, como defesa contra herbívoros, infecção por microrganismos patogênicos (Meyer et al. 2009, Hanhineva
46 DESENVOLVIMENTO SUSTENTÁVEL
et al. 2014, Tanwir et al. 2017), absorção de nutrientes, ou ainda, a redução do crescimento e estabelecimento de outras plantas (Taiz e Zeiger 2009, Inderjit et al. 2011, Yamauti et al. 2012).
Para o bom funcionamento do metabolismo primário, que envolve a fotossíntese, a respiração e o transporte de solutos, e o secundário, principalmente a via do ácido chiquímico, é vital o suprimento adequado de micronutrientes, que entram como catalisadores de inúmeras reações bioquímicas (Taiz e Zeiger 2009). O manejo inadequado dos nutrientes, portanto, é um dos principais fatores limitantes para o desenvolvimento da planta e da produção agrícola. O solo deve ser manejado de forma que a produtividade se sustente a longo prazo e de maneira constante, ao invés da busca pela máxima produtividade em curto prazo. Atingir rendimentos estáveis, com potencial de crescimento ao longo dos anos e a manutenção e/ou melhoria da fertilidade do solo é um dos principais desafios para alcançar o equilíbrio nutricional e a sanidade de plantas.
A busca pelo fornecimento de nutrientes em taxas adequadas, que acompanham os momentos de maior absorção e crescimento das plantas, tem sido tema de estudo nos últimos anos. Nesse sentido, Fayad et al. (2016) apresentam resultados de três estudos, cada um com uma cultivar de tomate em diferentes sistemas de condução, nos quais há acúmulo de biomassa ao longo do ciclo, expresso numa típica curva sigmoidal, que seguiu a mesma tendência de absorção dos nutrientes. Isso reforça que o crescimento e o acúmulo de nutrientes têm uma relação direta, colocando como desafio o fornecimento de nutrientes sincronizado com a absorção e a taxa de crescimento das plantas (Taxa Diária de Absorção - TDA) no programa de adubação das plantas. Fornecer nutrientes à planta, respeitando essa sincronização, possibilita diminuir o uso de adubos, aumentar a produtividade e colaborar com a saúde da planta. A análise visual da planta tem sido amplamente utilizada para a avaliação da deficiência e excesso de nutrientes minerais e de distúrbios fisiológicos, que ocorrem principalmente em flores, frutos e folhas nas diversas culturas (Fayad et al. 2016), assim como a análise da qualidade do solo é feita por meio de indicadores qualitativos associados ao método do perfil cultural do solo (Comin et al. 2016). O diagnóstico visual foliar de carência nutricional e o seu suprimento imediato tem permitido atacar o problema em tempo para evitar a perda total da safra, porém, quando determinado sintoma aparece no corpo da planta, denota um problema que já afetou a produção (Fayad et al. 2016). O desbalanço entre a disponibilidade de nutrientes no solo e a exigência das plantas pode afetar a absorção de nutrientes e, consequentemente, o desenvolvimento das plantas. Como exemplo, aplicações de K e Ca em quantidades excessivas via fertilizantes geralmente induzem à deficiência de Mg em plantas cultivadas, uma vez que a presença dos cátions K+ e Ca2+ inibem a absorção de Mg2+ pelas raízes das plantas. Além disso, a presença de Mn2+ na rizosfera também inibe a absorção de Mg2+ pelas raízes, mas tem pouco efeito
47 Fertilidade do solo e nutrição de plantas
sobre a absorção de K+ . Assim como elevados teores de P formam compostos, principalmente, com o Zn, o Fe e o Mn, deixando estes elementos em formas não disponíveis às plantas, os quais são essenciais para o funcionamento da fotossíntese. Isso supostamente reflete a especificidade contrastante dos transportadores responsáveis pela absorção de cada cátion (Marschner 2012). As exigências nutricionais das plantas e a extração de nutrientes podem variar de acordo com a espécie e o ambiente (Inderjit e Callaway 2003) e, a sua relação com o crescimento, pode ser diferente em razão do tipo de solo e do sistema de cultivo utilizado. O sistema de preparo convencional do solo (SPC), que se caracteriza pelo revolvimento do solo com aração e gradagem, ocasiona a degradação física, química e biológica do solo (Cunha et al. 2012, Loss et al. 2015), potencializando as perdas de água e nutrientes por erosão e o uso indiscriminado de fertilizantes (Panachuki et al. 2011, Altieri et al. 2011). Sistemas de cultivo com essas características facilitam o aparecimento de doenças e pragas, e consequentemente aumentam o uso de agrotóxicos. Sistemas conservacionistas de manejo do solo, com princípio de bases ecológicas, como a mobilização do solo restrita às linhas de plantio, o uso de diferentes espécies de plantas de cobertura em sistema de rotação de culturas e o parcelamento das adubações segundo a TDA, promovem a ciclagem de nutrientes, aumento dos teores de carbono orgânico total do solo e melhoria dos atributos relacionados à fertilidade do solo (Santos et al. 2017, Comin et al. 2018). O equilíbrio nutricional, portanto, é fundamental para que a planta atinja seu potencial máximo de desenvolvimento e produtividade, resista às doenças e possa minimizar o aparecimento de insetos-praga. A nutrição é peça chave para o ganho em produtividade, fazendo com que a planta seja capaz de resistir aos processos infecciosos através de metabolismo ajustado. Os efeitos dos nutrientes no crescimento e produção das plantas são, geralmente, explicados em relação às funções desses elementos no metabolismo vegetal. A nutrição também pode apresentar efeitos secundários sobre o crescimento e rendimento das plantas, induzindo mudanças no seu padrão de crescimento, morfologia, anatomia ou composição química, que podem aumentar ou diminuir a sua resistência ou tolerância a patógenos e pragas. Dependendo do nutriente, do estado nutricional, da espécie de planta e tipo de patógeno ou praga, a nutrição pode afetar a resistência ou tolerância da planta, e também a agressividade do patógeno (Marschner 2012).
A resistência pode ser aumentada por meio de alterações na anatomia, como maior grau de lignificação, alterações bioquímicas e fisiológicas que levam a uma maior produção de substâncias inibidoras ou repelentes e restrição de transferência de nutrientes necessários para o crescimento e/ ou desenvolvimento do patógeno. Embora a resistência e a tolerância sejam controladas geneticamente, elas são significativamente influenciadas pelos fatores do ambiente. A nutrição de plantas pode ser considerada como um fator que pode ser manipulado de forma relativamente fácil para mitigação de
48 DESENVOLVIMENTO SUSTENTÁVEL
estresses bióticos. Embora frequentemente não reconhecido, esse fator é um componente importante do controle de doenças. Por exemplo, aplicação de fertilizantes em diferentes quantidades e formas não só afeta diretamente o crescimento e composição das plantas, como tem efeitos sobre a atividade microbiana no solo e rizosfera. Isto indiretamente induz efeitos secundários e em cascata sobre resistência e tolerância a patógenos de raízes e brotos. Por outro lado, sintomas de deficiência nutricional em plantas podem ser induzidos por doenças radiculares ou pragas que prejudicam o crescimento e a atividade das raízes e, portanto, a absorção de nutrientes (Marschner 2012). Para elementos muito móveis, como N, P e K, as plantas apresentarão sintomas de deficiência nas partes mais velhas, enquanto para os de mobilidade limitada, como Ca, Mg e S, os sintomas serão percebidos nos ramos mais novos. Assim como a deficiência, o excesso de nutrientes também é responsável direto pela queda de sanidade das plantas (Zambiazzi et al. 2017). O excesso de adubação fosfatada pode induzir deficiência de Zn devido à interação desse nutriente com fosfato que é a forma de P absorvida pela planta. O excesso de N pode induzir o aumento de açúcares e aminoácidos na planta (Alves et al. 2003), que estão diretamente relacionadas à palatabilidade das plantas e o que pode ser um atrativo para os insetos sugadores.
Por meio dos sintomas exibidos pela planta pode-se fortalecer ou corrigir as causas com práticas adequadas de manejo, como a rotação de culturas, poda, forma de condução para maior entrada de luz e circulação de ar, arranjos espaciais, uso de indutores de resistência e entre outras práticas que melhoram a saúde e produtividade das culturas. A diminuição das condições estressantes e dos desequilíbrios nutricionais contribuem diretamente para o aumento da produtividade e, acima de tudo, promovem a saúde vegetal.
CONSIDERAÇõES FINAIS
A fertilidade do solo e a utilização de sistemas conservacionistas de produção desempenham um papel fundamental na agricultura sustentável e na sanidade das plantas. Se não trabalhada de forma correta, pode comprometer a produção tanto quantitativamente quanto qualitativamente. Dessa forma, o correto manejo da fertilidade do solo, mantendo níveis de pH e a disponibilidade de nutrientes em faixas ideias para as culturas, proporciona adequada nutrição das plantas, refletindo em maiores produtividades. Além disso, é importante destacar que “plantas bem nutridas são plantas saudáveis” e, consequentemente, apresentam menor suscetibilidade ao ataque de pragas e doenças, que podem comprometer a produtividade e a qualidade do produto final.
49 Fertilidade do solo e nutrição de plantas
REFERêNCIAS BIBLIOGRÁFICAS
Alfaia SS, Uguen K (2013) Fertilidade e manejo do solo. In: Moreira FMS, Cares JE, Zanetti R, Stürmer SL (eds) O ecossistema solo: componentes, relações ecológicas e efeitos na produção vegetal. Editora UFLA, Lavras, pp 75-90.
Altieri MA, Lana MA, Bittencourt HV et al. (2011) Enhancing Crop Productivity via Weed Suppression in Organic No-Till Cropping Systems in Santa Catarina, Brazil. Journal of Sustainable Agriculture, 35(8):855-869.
Alvarez VVH et al. (2007) Enxofre. In: Novais RF, Alvarez VVH, Barros NF et al. (Eds). Fertilidade do solo. Viçosa, SBCS, pp.595-644.
Alves E et al. (2003) Avaliações fisiológicas e bioquímicas de plantas de aguapé (Eichhornia crassipes) cultivadas com níveis excessivos de nutrientes, Planta daninha, pp.27-35.
Barker AV, Eaton TE (2015) Zinc. In: Barker AV, Pilbeam DJ (eds) Handbook of plant nutrition, 2nd edn. CRC press, Boca Raton, pp.537-566.
Barker AV, Stratton ML (2015) Iron. In: Barker AV, Pilbeam DJ (eds) Handbook of plant nutrition, 2nd edn. CRC press, Boca Raton, pp.399-426.
Burkhead JL et al. (2009) Copper homeostasis. New Phytologist, 182(4):799816.
Camacho-Cristóbal JJ, Rexach J, González-Fontes A (2008) Boron in plants: deficiency and toxicity. Journal of Integrative Plant Biology, 50(10):1247-1255. Chen W, He ZL, Yang XE, Mishra S, Stoffella PJ (2010) Chlorine nutrition of higher plants: progress and perspectives. Journal of Plant Nutrition, 33(7):943952.
Comin JJ, Fayad JÁ, Kurtz C, Mafra AL, Curmi P (2016) Guia prático de avaliação participativa da qualidade do solo em Sistema de Plantio Direto de Hortaliças (SPDH). Epagri, 11p.
Connolly EL, Guerinot ML (2002) Iron stress in plants. Genome Biology, 3(8):reviews1024-1–reviews1024.4.
CQFS-RS/SC (2016) Manual de calagem e adubação para os estados do Rio Grande do Sul e Santa Catarina. Sociedade Brasileira de Ciência do Solo-Núcleo Regional Sul. 404p.
Cunha EQ et al. (2012) Atributos físicos, químicos e biológicos de solo sob produção orgânica impactados por sistemas de cultivo. Revista Brasileira de Engenharia Agrícola e Ambiental, 16(1):56-63.
Dechen AR, Nachtigall GR (2007) Elementos requeridos à nutrição de plantas. In: Novais SRF et al. (Eds). Fertilidade do solo. Viçosa: SBCS, pp.91-132. Faquin, V. (2005). Nutrição mineral de plantas, Lavras: UFLA / FAEPE. 186p.
Fayad JA, Comin JJ, Bertol I (2016) Sistema de Plantio Direto de Hortaliças (SPDH): O cultivo do tomateiro. Epagri, Boletim Didático, 131, 91p.
Ferreira MMM (2012) Sintomas de deficiência de macro e micronutrientes de plantas de milho híbrido BRS 1010. Revista Agroambiente, 6(1):74-83.
Furlani AMC (2004) Nutrição mineral. In: Kerbauy GB. Fisiologia vegetal. São Paulo: Guanabara Koogan, pp.40-75.
Garnica M, Houdusse F, Yvin JC et al. (2009) Nitrate modifies urea root uptake and assimilation in wheat seedlings. Journal of the Science Food and Agriculture, 89(1):55-62.
50 DESENVOLVIMENTO SUSTENTÁVEL
Garnica M, Houdusse F, Zamarreno AM et al. (2010) Nitrate modifies the assimilation pattern of ammonium and urea in wheat seedlings. Journal of the Science Food and Agriculture, 90 (3):357-369.
Hafeez B, Khanif YM Saleem M (2013) Role of zinc in plant nutrition - A review. American Journal of Experimental Agriculture, 3(2):374-391.
Hammond-Kosack K, Jones JDG (2000) Response to plant pathogens. In: Buchanan BB, Gruissem W, Jones RL. (Eds.). Biochemistry & Molecular Biology of Plants. Rockville: American Society of Plant Physiologists, pp.1102-1156.
Hänsch R, Mendel RR (2009) Physiological functions of mineral micronutrients (Cu, Zn, Mn, Fe, Ni, Mo, B, Cl). Current Opinion in Plant Biology, 12(3):259266.
Harper JE. (1994) Nitrogen metabolism. In: Boote KJ, Bennett JM, Sinclair TR et al. Physiology and determination of crop yield. Madison: ASA/CSSA/SSSA, pp.285-302.
Harrington JM, Duckworth OW, Haselwandter K (2015) The fate of siderophores: antagonistic environmental interactions in exudate-mediated micronutrient uptake. Biometals, 28:461-472.
Inderjit & Callaway RM (2003) Experimental designs for the study of allelopathy. Plant and Soil, 256(1):1-11.
Inderjit, Wardle DA, Karban K, Callaway RM (2011) The ecosystem and evolutionary contexts of allelopathy. Trends in Ecology and Evolution, 26(12): 655-662.
Jeong J, Guerinot ML (2009) Homing in on iron homeostasis in plants. Trends in Plant Science, 14(5):280-285.
Kim SA, Guerinot ML (2007) Mining iron: iron uptake and transport in plants. FEBS Letters, 581(12):2273-2280.
Kopsell DA, Kopsell DE, Hamlin RL (2015) Molybdenum. In: Barker AV, Pilbeam DJ, Handbook of plant nutrition, 2ed. CRC press, Boca Raton, pp.487-510.
Kopsell DE, Kopsell DA (2015) Chlorine. In: Barker AV, Pilbeam DJ, Handbook of plant nutrition, 2nd edn. CRC press, Boca Raton, pp.347-366.
Lopes AS (1998) Manual internacional de fertilidade do solo. 2eds. Ampliada e revisada. Piracicaba: Potafos, 177p.
Loss A, Basso A, Oliveira BS et al. (2015) Carbono orgânico total e agregação do solo em sistema de plantio direto agroecológico e convencional de cebola. Revista Brasileira de Ciência do Solo, 39(4):1212-1224.
Malavolta E (1979) ABC da Adubação. São Paulo: Editora Agronômica CERES Ltda, 292p.
Malavolta E (2005) Potássio: absorção, transporte e redistribuição na planta. In: Yamada T, Roberts TL. Potássio na agricultura brasileira, Piracicaba, Potafos, pp.179-238.
Malavolta E (2006) Manual de nutrição mineral de plantas. São Paulo, Agronômica Ceres. 631p.
Marschner H (2012) Mineral Nutrition of Higher Plants. 3ed. San Diego: Academic Press. 651p.
Meyer SLF, Rice CP, Zasada IA (2009) DIBOA: Fate in soil and effects on rootknot nematode egg numbers. Soil Biology & Biochemistry, 41(7):1555-1560.
51 Fertilidade do solo e nutrição de plantas
Millaleo R et al. (2010) Manganese as essential and toxic element for plants: transport, accumulation and resistance mechanisms. Journal of Soil Science and Plant Nutrition, 10(4):470-481.
Myrold DD (1998) Transformations of nitrogen. In: Sylvia et al. (Ed.). Principles and aplications of soil microbiology. New Jersey: Prentice Hall, pp.259-294
Nagajyoti PC, Lee KD, Sreekanth TVM (2010) Heavy metals, occurrence and toxicity for plants: a review. Environmental Chemistry Letters, 8(3):199-216.
Panachuki E et al. (2011) Perdas de solo e de água e infiltração de água em Latossolo vermelho sob sistemas de manejo. Revista Brasileira de Ciência do Solo, 35(5):177-1786.
Rocha JHT, Gonçalves JLM, Godinho TO, Souza Filho LFSS (2015) Nutrição e fertilização com enxofre e uso de gesso em plantações de eucalipto. Instituto de pesquisas e estudos florestais, 17p.
Rout GR, Sahoo S (2015) Role of iron in plant growth and metabolism. Reviews in Agricultural Science, 3:1-24.
Santos LH, Loss A, Lourenzi CR et al. (2018) Total nitrogen and humic substances in aggregates of soils with onion crops under no-tillage and conventional systems. Revista Colombiana de Ciencias Hortícolas, 12(1):166-179.
Schulze DG (1989) Na introduction to soil mineralogy. In: Dixon JB, Weed SB. (Eds.). Minerals in soil environments. SSSA, Madison, pp.1-34.
Stipp SR, Casarin VA (2010) Importância do enxofre na agricultura brasileira. Informações agronômicas. Piracicaba, Potafós, 129:14-20.
Prates HS, Junior JL, Moraes MF (2006) O enxofre como nutriente e agente de defesa contra pragas e doenças. Piracicaba, Potafós, 115:8-9.
Taiz L, Zeiger E (2004) Fisiologia vegetal. Porto Alegre: Artmed, 719p.
Tanwir F, Dionisio G, Adhikari KB, Fomsgard IS (2017) Biosynthesis and chemical transformation of benzoxazinoids in rye during seed germination and the identification of a rye Bx6-like gene. Phytochemistry, 140:95-107.
Werle R, Garcia RA, Rosolem CA (2008) Lixiviação de potássio em função da textura e da disponibilidade do nutriente no solo. Revista Brasileira de Ciência do Solo, 32(8):2297-2305.
Wimmer MA, Goldberg S, Gupta UC (2015) Boron. In: Barker AV, Pilbeam DJ Handbook of plant nutrition, 2nd ed. CRC press, Boca Raton, pp.305-346
Yamauti MS, Alves PLCA (2012) Ácido hidroxâmico sobre a germinação de sementes de espécies de plantas daninhas. XXVIII Congresso Brasileiro da Ciência das Plantas Daninhas, Campo Grande, pp.492-496.
Yruela I (2015) Copper. In: Barker AV, Pilbeam DJ Handbook of plant nutrition, 2nd edn. CRC press, Boca Raton, pp.367-398.
Yusuf M, Fariduddin Q, Hayat S, Ahmad A (2011) Nickel: an overview of uptake, essentiality and toxicity in plants. Bulletin of Environmental Contamination and Toxicology, 86(1):1-17.
Zambiazzi EV et al. (2017) Desempenho agronômico e qualidade sanitária de sementes de soja em resposta à adubação potássica. Revistta de Ciências Agrárias, 40(3):543-553.
52 DESENVOLVIMENTO SUSTENTÁVEL
MANEjO ECOLÓGICO DE PRAGAS E DOENÇAS NA PRODUÇÃO AGROALIMENTAR
Aline C. Velho1, Alex S. Poltronieri1, Marciel J. Stadnik1, Pedro Mondino2
1 Universidade Federal de Santa Catarina, Centro de Ciências Agrárias, Programa de Pós-graduação em Agroecossistemas, Rod. Admar Gonzaga, 1346, 88034-001, Florianópolis-SC, Brasil. E-mail: alinecristinav@gmail.com
2 Universidad de la Republica, Facultad de Agronomía, Departamento de Protección Vegetal, Av. Garzón, 780, 11900, Montevideo, Uruguay. E-mail: pmond13@gmail.com
INTRODUÇÃO
O desenvolvimento agrícola de um país é importante, porém enfrenta grandes desafios. Não se trata apenas de proporcionar crescimento, modernizar a agricultura e aumentar a produtividade, mas sim, de promover mudanças na relação entre o homem e a natureza. Tais mudanças envolvem a utilização dos recursos ambientais e a produção de alimentos sem comprometer as necessidades das gerações futuras.
Essa questão nos remete ao conceito de desenvolvimento sustentável, apresentado pela primeira vez no documento “Our common future” pela ONU (Brundtland et al. 1987). O conceito até hoje é muito discutido, principalmente porque não é limitado somente à questão da preservação dos recursos naturais, mas também às questões econômicas, políticas e sociais. O que pode ser considerado natural, uma vez que, o desenvolvimento sustentável propriamente dito está em constante evolução. Por um lado, sua aplicação visa substituir o modelo de agricultura produtivista (pouco preocupada com as questões ambientais), e por outro, que o ambiente seja considerado um fator de produção tão importante quanto a terra, o capital e o trabalho (Bajwa e Kogan 2002). Com uma maior compreensão da sociedade sobre a importância da sustentabilidade, houve um aumento na demanda por alimentos produzidos dentro de um modelo socioambiental mais consciente. Atualmente, existe uma grande preocupação com o impacto da utilização dos agrotóxicos na agricultura, tanto na saúde da população como também no meio ambiente. Nesse sentido, agricultores e profissionais da área depararam-se com um grande desafio, o de produzir alimentos com qualidade, rentabilidade e livres de agrotóxicos (Dal Soglio e Kubo 2016). Mesmo o conceito de qualidade passou por uma evolução importante, de modo que já não se refere à mera estética do produto (cor, aroma, sabor), mas inclui outros aspectos como a segurança
Stadnik MJ, Velho AC, Zorrilla SE (eds.) Desenvolvimento Sustentável na Produção Agroalimentar
53
4
alimentar (os alimentos devem ter segurança química e biológica), e abrange todo o processo produtivo onde todos os produtos devem ser produzidos através de métodos ecologicamente corretos e socialmente justos.
O uso de agrotóxicos na produção de alimentos proporcionou uma série de avanços e impactos na agricultura. Este processo de modernização que ocorreu em meados do século XIX até o início do século XX marcou uma série de descobertas científicas e alavancou a “Revolução Verde” (Deguine et al. 2017). O termo surgiu em meados da década de 50, em um contexto de otimismo e com uma série de inovações tecnológicas que permitiram um aumento na produtividade por meio do uso intensivo de fertilizantes, genótipos melhorados, mecanização e agrotóxicos.
Ao longo dos anos a utilização destes agrotóxicos e também a adoção das novas tecnologias, como o uso intensivo da monocultura e o melhoramento genético, proporcionaram de certa forma, maior facilidade e rendimento da produção agrícola. No entanto, a falta de conhecimento sobre a ecologia, fisiologia e interação das espécies com o ecossistema, fez com que o uso dessas técnicas, fossem os principais causadores da perda das características naturais das plantas (os híbridos substituíram variedades locais adaptadas). Como consequência, além de ocasionar uma maior dependência de insumos, as novas tecnologias também resultaram em uma série de desequilíbrios ambientais, maior suscetibilidade das plantas a estresses nutricionais e hídricos e, menor resistência às pragas e doenças (Primavesi 1990).
Os resultados sociais e ambientais do uso intensivo de técnicas preconizadas na agricultura convencional não foram os melhores, o que tem levado a insustentabilidade desse sistema de produção (Altieri et al. 2003, Dal Soglio e Kubo 2016). Atualmente, muitos agricultores ainda resistem ou até mesmo desconhecem outros sistemas alternativos de produção. Na tentativa de minimizar as perdas, o uso de agrotóxicos tem se intensificado a cada ano, colocando o Brasil entre os maiores consumidores de agrotóxicos do mundo. O controle com fungicidas e inseticidas sintéticos ainda é a principal estratégia para o manejo de pragas e doenças na produção agroalimentar.
Nesse contexto, o manejo ecológico como forma de controle de pragas e doenças passou a ter maior importância em todo o mundo. A chave para esse sistema é estabelecer uma série de procedimentos que sejam favoráveis ao crescimento e desenvolvimento das plantas e desfavoráveis a evolução dos patógenos e epidemias. Dessa maneira, há maior estímulo às práticas que possam aumentar a biodiversidade e ao mesmo tempo respeitar a interação dos patógenos e plantas com o meio ambiente (Primavesi 1990).
1. PRINCÍPIOS RELATIVOS AO CONTROLE E MANEjO DE PRAGAS E DOENÇAS
O controle de doenças de plantas foi definido, no início do século XX por Whetzel como a prevenção dos prejuízos causados por uma doença (Kimati
54 DESENVOLVIMENTO SUSTENTÁVEL
et al. 2011), ou seja, considerando apenas os aspectos econômicos. Os princípios de Whetzel abordavam a ação do homem sobre o patógeno e o hospedeiro, enquanto que o efeito do ambiente era totalmente ignorado. Portanto, tais princípios não poderiam abranger satisfatoriamente todas as medidas de controle.
Anos mais tarde, surgiu uma compreensão biológica para o controle, sendo esta, definida como a redução na incidência ou severidade de uma doença (NRS 1969). Esse significado biológico foi de fundamental importância, uma vez que, pragas e doenças dificilmente podem ser controladas com eficiência sem o conhecimento da sua etiologia, condições climáticas a que estão expostas, características do ciclo das relações patógeno-hospedeiro e dos métodos de controle disponíveis (Kimati et al. 2011).
O termo “controle integrado” foi criado em um contexto mais específico para a área da entomologia. Foi proposto pela primeira vez por Hoskins et al. (1939), mas somente em 1959 foi abordado de forma mais objetiva, onde foi definido como o controle de pragas que combina e integra os controles químico e biológico (Stern et al. 1959). Posteriormente, para tornar o conceito mais abrangente, a FAO (1968) adotou o termo como “sistema de manejo de organismos nocivos que utiliza todas as técnicas e métodos apropriados da maneira mais compatível possível para manter as populações destes organismos em níveis abaixo daqueles que causam dano econômico”. Com essa definição, concluiu-se que no controle integrado deveria ocorrer uma integração harmônica de todas as técnicas aos elementos naturais limitantes e reguladores do ambiente. No entanto, o que ocorreu na prática foi a integração de programas tradicionais de erradicação química (de Paula Júnior et al. 2005). Na década de 70, o termo “manejo integrado de doenças” foi proposto por Chiarappa (1974), especificamente para a área da fitopatologia. A utilização do termo manejo surgiu da necessidade de se reduzir, substituir e/ou eliminar o uso de agrotóxicos, ou seja, evitar a chamada “síndrome do pesticida” e a “síndrome da resistência”, descritas por Doutt e Smith (1971) e Zadoks e Schein (1979), respectivamente. Dessa forma, o sistema de manejo integrado se propõe a utilizar todas as técnicas disponíveis, dentro de um programa unificado, de tal modo a manter a população de pragas e doenças de plantas a um nível inferior ao limiar de dano econômico, e a minimizar os efeitos deletérios ao meio ambiente (NRS 1969, Bajwa e Kogan 2002).
Uma das características mais notáveis do manejo integrado, é que ele foi definido para cada situação particular, buscando sempre o estabelecimento de um agroecossistema economicamente e ambientalmente sustentável (Bajwa e Kogan 2002, Mondino 2004). O manejo requer um monitoramento constante da população dos insetos nocivos e de seus inimigos naturais além da incidência de fitopatógenos, tudo isso combinado com as tomadas de decisões do produtor durante todo o ciclo da cultura (de Paula Júnior 2005).
55 MANEJO ECOLÓGICO
Nesse contexto, os termos “controle” e “manejo” diferenciam-se pelo fato de que o primeiro, visa somente o limiar de dano econômico e a total dominância do agroecossistema, enquanto que o manejo, leva em conta além da questão econômica, todas as questões ecológicas e sociais dos produtos agrícolas que são utilizados e produzidos. O manejo admite que as pragas e doenças são organismos intrínsecos dos agroecossistemas.
2. MANEjO ECOLÓGICO DE PRAGAS E DOENÇAS DE PLANTAS
O termo manejo ecológico de pragas e doenças passou a ser muito utilizado no século XX, principalmente após alguns fracassos relacionados aos métodos de manejo utilizados na agricultura convencional. O manejo ecológica implica uma concepção filosófica diferente da proteção vegetal (Mondino 2004). Seu principal objetivo é a redução da capacidade das pragas e doenças de causarem perdas significativas da produção sem perturbação do equilíbrio ambiental, ao mesmo tempo em que se procura reduzir a dependência de insumos externos aos agroecossistemas (Primavesi 1990, Dal Soglio e Kubo 2016). O sistema procura aprimorar os processos ecológicos e as interações entre comunidades vegetais e animais dentro do agroecossistema, com vista a otimizar o funcionamento de uma maneira sustentável. Assim, considerase que populações de patógenos, insetos praga e plantas invasoras não são “inimigas a destruir”, mas sim “componentes do agroecossistema”, portanto deve-se conviver com elas (Mondino 2004).
Muitos referem-se ao manejo ecológico como a solução para muitos dos problemas gerados na agricultura convencional, uma vez que, não são os efeitos que devem ser atacados, mas as causas que devem ser combatidas. O alicerce para esse sistema é o manejo do ambiente de interação do patógeno em favor do hospedeiro através da utilização de estratégias adequadas para cada situação específica. Nesse caso, há a aplicação racional dos princípios de controle propostos por Whetzel (1929), tais como: a erradicação e a exclusão que atuam predominantemente sobre o patógeno; a proteção, a imunização e a terapia que atuam sobre o hospedeiro (Fig. 1); e a evasão e regulação que estão relacionadas aos fatores ambientais e tornam os princípios de controle mais abrangentes, permitindo uma visão mais global da natureza da doença.
Para o estabelecimento de estratégias eficientes de controle é fundamental o conhecimento do ciclo de vida e das características intrínsecas do patógeno e do hospedeiro. Conhecer as vulnerabilidades do patógeno é essencial para interromper o ciclo das relações patógeno-hospedeiro, no qual incluem eventos de sobrevivência, disseminação, infecção, colonização e reprodução (Fig. 1). Além disso, é imprescindível que se compreenda os fatores ambientais que influeciam as doenças e ocasionam danos econômicos às culturas.
O ciclo representado na Figura 1, pode ocorrer uma vez durante a mesma estação de cultivo, sendo denominado monociclo, ou ocorrer sucessivas
56 DESENVOLVIMENTO SUSTENTÁVEL
vezes a partir da primeira geração de um patógeno estabelecido na cultura, policiclo. Neste caso, o patógeno estabelecido na cultura proveniente desta primeira geração irá representar o ciclo primário, ou quando origina-se a partir de gerações subsequentes em um mesmo ciclo da cultura, será o ciclo secundário (Amorim e Pascholati 2011).

Figura 1. Processos das relações patógeno-hospedeiro onde atuam os princípios de controle de Whetzel (Fonte: Stadnik et al. 2009).
O primeiro processo do ciclo primário corresponde a fase de sobrevivência do patógeno (inóculo), ou seja, é a fase que garante a sobrevivência do mesmo sob condições climáticas desfavoráveis ou ausência do hospedeiro. Durante essa fase, medidas de controle baseadas na erradicação (eliminação do patógeno de uma área em que foi introduzido), são as mais eficientes, de modo a eliminar plantas hospedeiras, vetores e estruturas de sobrevivência dos patógenos. As técnicas utilizadas na erradicação geralmente não eliminam totalmente o patógeno da área, mas reduzem o inóculo inicial e o desenvolvimento das epidemias (Stadnik et al. 2009). Dentro do manejo ecológico, técnicas como a eliminação de plantas doentes “roguing”, a rotação de culturas, o tratamento térmico de sementes, a inundação ou solarização do solo e o emprego de plantas armadilhas ou antagonistas são altamente eficientes. Na fase de disseminação do patógeno, a principal medida de controle é a exclusão (prevenção da entrada de um patógeno numa área ainda não infestada). Os patógenos possuem inúmeras formas de se disseminar no am-
57 MANEJO ECOLÓGICO
biente, mas esta vai depender das características intrínsecas de cada um. Por exemplo, a liberação de ascósporos de Venturia inaequalis, agente causal da sarna da macieira, ocorre normalmente nos meses de agosto a outubro, no entanto, em condições de inverno ameno a liberação pode ser antecipada e ocorrer em julho (Stadnik et al. 2009). Além disso, a ejeção de ascósporos deste mesmo patógeno ocorre de forma ativa quando em contato com a água, enquanto que para outros patógenos é necessário força mecânica, correntes de ar ou respingos de água para disseminação. Neste caso, patógenos que são disseminados a longas distâncias não são efetivamente controlados na exclusão. Nesse contexto, métodos de controle baseados neste princípio visam a utilização de práticas que impossibilitem a ação de agentes disseminadores. O vazio sanitário é uma técnica muito comum na soja para o manejo da ferrugem asiática (Phakopsora pachyrhizi), onde por um período mínimo 60 dias as áreas de plantio permanecem sem a cultura e plantas voluntárias (Embrapa 2019). Além deste, o uso de barreiras, quarentena, utilização de sementes e mudas certificadas e uso de cultura de tecidos para propagação, também são bastante utilizados.
Na fase em que ocorre o encontro entre as partes suscetíveis da planta e o inóculo do patógeno (deposição e pré-penetração), atua o princípio da proteção. A proteção consiste na interposição de uma barreira entre o patógeno e o hospedeiro. Frequentemente, medidas de controle baseadas neste princípio envolvem o uso fungicidas, inseticidas, bactericidas, entre outros. Mas no manejo ecológico, o ideal é que se escolha técnicas que não provoquem danos à planta ou desencadeiem desequilíbrios ecológicos. Podemos citar como exemplo, o tratamento pós-colheita com cera de carnaúba, que evita a perda de água dos frutos e ao mesmo tempo impede a germinação de esporos como da Monilinia fructicola, agente causal da podridão parda do pessegueiro (Gonçalves et al. 2010).
Na impossibilidade de impedir a entrada do patógeno no hospedeiro, terá início a fase de infeção e colonização. Nessa fase, atua a medida baseada na imunização, que consiste no uso de uma população de plantas imunes ou altamente resistentes em uma área infestada com o patógeno. A aplicação deste princípio é eficiente e geralmente tem baixo custo de produção. No entanto, pode acarretar alterações indesejáveis no potencial produtivo ou valor comercial do produto. Além da resistência genética, outro método de controle que atua pelo princípio da imunização é a técnica conhecida como pré-imunização ou proteção cruzada, a qual vem sendo usada com sucesso no controle do vírus da tristeza dos citros (CTV) (Gonçalves et al. 2018).
A resistência pode ser constitutiva ou induzida, sistemática ou local, qualitativa ou quantitativa. Pode ser introduzida a partir de variedades selvagens ou através de técnicas de melhoramento vegetal. A eficácia delas vai depender muito do tipo de resistência genética envolvida. Por exemplo, a resistência qualitativa, associada com a habilidade de genes maiores controlarem a
58 DESENVOLVIMENTO SUSTENTÁVEL
infecção ocasionada por raças específicas de um patógeno, é altamente eficaz. Porém, devido a constante evolução de alguns patógenos em meio as práticas agrícolas modernas, ela perde sua eficiência em poucos anos. Por outro lado, a resistência quantitativa, controlada por múltiplos genes de efeito menor na planta, é menos eficaz em reduzir as epidemias, mas é mais duradora devido a menor pressão de seleção sobre os patógenos (Thurow et al. 2018).
A indução de resistência é outra alternativa moderna e eficiente que demonstra ser menos agressiva à saúde e aos agroecossistemas (Stadnik e Maraschin 2004, Siah et al. 2018). Consiste na ativação de mecanismos latentes de resistência em uma planta através de tratamentos com agentes externos que podem ser bióticos ou abióticos e sem qualquer alteração no genoma da planta (Stadnik e Maraschin 2004, Cavalcanti et al. 2015, Dallagnol et al. 2018). Compostos naturais como extratos de plantas, polissacarídeos algais, além de metabólitos microbianos podem atuar indiretamente através da elicitação dos mecanismos defesa na planta. Os indutores de resistência são eficazes no controle de uma ampla gama de patógenos, incluindo herbívoros, vírus, bactérias, fungos oomicetos e nematoides (Siah et al. 2018).
Uma vez que o patógeno já estabeleceu uma íntima relação com o hospedeiro (após a infecção, colonização e reprodução) e a doença já está presente, o princípio da terapia é utilizado para restabelecer a sanidade da planta. O uso de fungicidas sistêmicos é um dos métodos mais utilizados, mas com vista aos métodos mais adequados ao manejo ecológico, podemos citar o tratamento térmico e a remoção de partes doentes da planta através da poda e/ ou cirurgia em plantas perenes (Kimati et al. 2011).
Por fim, os princípios da evasão e regulação resultam na interação de três fatores: planta, patógeno e ambiente. Medidas de controle baseadas na evasão visam garantir uma fuga em relação ao período crítico de uma cultura e ao desenvolvimento de um patógeno, ou seja, favorecer uma assincronia entre o hospedeiro suscetível, um patógeno agressivo e um ambiente favorável (Kimati et al. 2011). Essa medida pode ser obtida através de alterações na época, local ou sistema de plantio. É uma abordagem mais complexa, e a eficiência dela requer um amplo conhecimento acerca da suscetibilidade do hospedeiro em diferentes estágios fenológicos, e também da característica do patógeno. Por exemplo, alterações espaciais são mais eficientes para patógenos de solo, como nematóides. Por outro lado, alterações na época e sistema de plantio são mais eficientes para doenças policíclicas, onde o inóculo primário não é determinante para a epidemia da doença. Na ausência de variedades resistentes, a evasão é a primeira opção a ser utilizada, seja ela em grandes ou pequenas áreas.
O princípio da regulação possibilita a alteração de alguns fatores ambientais como temperatura e umidade. Este princípio é extremamente importante em cultivos protegidos. O uso da plasticultura tem assumido um grande papel, pois propicia o controle de doenças e de insetos pela manipulação do
59 MANEJO ECOLÓGICO
ambiente (Vida 2004). Atualmente existem plásticos capazes de filtrar raios UV (<360 nm) que são essenciais para a esporulação de alguns patógenos (Paul et al. 2005). O manejo da irrigação, adubação equilibrada e a refrigeração (frutas e hortaliças), também são métodos que fazem parte desta medida de controle.
2.1 Modelo de pirâmide ecológica
O manejo ecológico de pragas e doenças é caracterizado como um processo que deve ser definido para cada situação específica. A primeira e mais importante etapa na implementação deste sistema é o planejamento. Ele prevê os problemas potenciais que podem surgir durante o desenvolvimento da cultura e as possíveis táticas preventivas. Em um segundo estágio de prevenção, todas as ferramentas disponíveis são colocadas em prática (por exemplo, uso de variedades resistentes, eliminação de inóculo ou abrigo de pragas, escolha do local e da época de plantio, rotação de cultura, etc). Por fim, a chamada etapa de análise, que permite determinar a necessidade ou não, de realizar intervenções específicas de controle. Caso a necessidade tenha sido definida, a medida mais eficiente e econômica deve ser escolhida. Elas devem ser aplicadas de forma adequada e no momento oportuno, a fim de otimizar a eficácia, bem como a redução de efeitos adversos.
O modelo de pirâmide ecológica (Fig. 2) é muito utilizado na etapa de planejamento, pois é uma maneira de demonstrar a importância da utilização das diversas práticas de manejo para reduzir ou até mesmo eliminar o uso do controle químico. Na pirâmide, quanto mais na base o método de manejo estiver, maior será a eficiência, abrangência, estabilidade e sustentabilidade da atividade produtiva. Neste caso, o uso de biocidas, localizado no topo, deve ser evitado ou deverá ser utilizado estritamente como último recurso.
BIOCIDAS
CONTROLE SELETIVO
CONTROLE BIOLÓGICO
DESENHO E MANEjO DO AGROECOSSISTEMA
RESISTêNCIA GENÉTICA E NUTRIÇÃO
ZONEAMENTO AGROECOLÓGICO
Figura 2. Métodos de manejo ecológico baseado em um modelo de pirâmide.
60 DESENVOLVIMENTO SUSTENTÁVEL
2.1.1 Zoneamento agroecológico
O zoneamento agroecológico é considerado a base de todo o processo. Ele consiste no processo de identificação de áreas relativamente homogêneas, caracterizadas em função de fatores físicos (clima, solo, relevo), biológicos (flora e fauna) e socioeconômicos (presença do homem e suas atividades). De acordo com a FAO (1997), os parâmetros específicos do zoneamento agroecológico são centralizados nas exigências climáticas e edáficas da espécie cultivada e também no sistema de manejo utilizado. Neste caso, é importante que se conheça as particularidades de cada zona para melhorar o uso da terra ou para incrementar a produção sem a degradação dos recursos naturais.
No zoneamento agroecológico, as espécies cultivadas quando introduzidas em novos locais podem ter vantagens no ponto de vista fitossanitário, pois a probabilidade de ocorrência de doenças e pragas é muito menor. Ele deve ser empregado não apenas visando a escolha das melhores condições edafoclimáticas para o desempenho de uma cultura, mas também para seleção de regiões que não predispõem a incidência de doenças e pragas. Os insetos são dependentes de fatores ambientais para o desenvolvimento de elevadas populações. Dados como balanço hídrico, temperatura e umidade relativa, permitem a confecção de climogramas que possibilitam a avaliação do efeito das condições ambientais sobre o potencial biótico de um inseto praga e seus inimigos naturais (Milanez et al. 2005). Deste modo, é possível empregar a resistência proporcionada pelo ambiente. Dados climáticos como a temperatura associadas ao estudo da biologia do inseto, podem fornecer subsídios para aplicação de modelos matemáticos para prever a ocorrência de elevadas populações de insetos praga (Monteiro e Hickel 2004).
Estratégias de controle seletivas e menos impactantes ao ambiente e a organismos não alvo podem ser adotadas a partir destes modelos. No caso de doenças, ocorre algo similar como o monitoramento das condições climáticas, ocorrência de chuvas, horas de molhamento foliar, quantificação de esporos através do uso de armadilhas caça-esporos, etc. Todas essas medidas contribuem para a tomada de decisão sobre o melhor método de manejo.
Sob o ponto de vista econômico, a função do zoneamento agroecológico é também proporcionar um instrumento de orientação para a execução de políticas públicas, subsídio para execução de planos, programas e projetos regionais para exploração dos recursos naturais. Assim, o zoneamento favorece o desenvolvimento harmônico sustentável para o meio rural.
2.1.2 Resistência genética e nutrição
O uso da resistência genética é uma das estratégias mais utilizadas no manejo de pragas e doenças (Thurow et al. 2018). Possui um baixo impacto ambiental e, dependendo das condições de manejo, oferece durabilidade e especificidade. Em algumas culturas este é o único meio de controle disponível, além de ser o mais econômico e de baixo impacto (van Bruggen e Finckh 2016).
61 MANEJO ECOLÓGICO
A resistência é a capacidade de uma planta evitar ou retardar a entrada ou desenvolvimento de um patógeno em seus tecidos com ações morfológicas ou bioquímicas (Agrios 2005). Sob ponto de vista entomológico, uma planta é considerada resistente quando sua constituição genotípica é menos danificada que outra em igualdade de condições (Lara 1991), mantendo pragas em níveis inferiores ao de dano econômico (Gallo et al. 2002).
Diversos trabalhos demostram que a resistência genética das plantas está relacionada principalmente aos aumentos significativos das taxas fotossintéticas e aos mecanismos que atuam como barreira física e tóxica aos micro-organismos, tais como, produção de papilas, acúmulo de silício em locais de penetração, acúmulo de carboidratos nas folhas, ceras, camadas adicionais de células epidérmicas, aumento da quantidade de fibras, redução da concentração de nutrientes e alteração na produção de enzimas relacionadas com a resistência (Cavalcanti et al. 2015, Dallagnol e Araujo Filho 2018). Assim, para o melhor desempenho das culturas, muitos agricultores optam por utilizar cultivares resistentes, dependendo do seu interesse.
A disponibilidade de fontes adequadas de genes de resistência é um pré-requisito básico para programas de melhoramento que têm como objetivo desenvolver cultivares com níveis aceitáveis de produtividade, adaptação e caracteres agronômicos favoráveis. Em plantas cultivadas há quatro importantes grupos de fontes de genes de resistência: cultivares elite, coleções de germoplasma, espécies silvestres e mutações (Thurow et al. 2018).
A quebra da resistência genética por populações de patógenos é um dos maiores desafios, pois a natureza está sempre evoluindo e se adaptando.
Populações de patógenos possuem mecanismos de variabilidade que permitem a sua adaptação a condições adversas. Muitas modificações na fisiologia das plantas poderão alterar os mecanismos de resistência genética obtidas por métodos tradicionais ou por engenharia genética. Assim, para o desenvolvimento de estratégias de uso de genes de resistência visando à resistência durável, é fundamental um bom entendimento dos processos que governam a evolução e a estrutura genética de populações do patógeno (McDonald 2014).
A escolha do melhor método de seleção leva em consideração, principalmente, a natureza genética da resistência, se qualitativa ou quantitativa, e o tipo de reprodução do hospedeiro, se autógama ou alógama (Agrios 2005). A seleção de genes de interesse por meio de técnicas genômicas e de bioinformática têm possibilitado a caracterização das diversas funções gênicas que podem afetar a virulência, a formação de conídios e o crescimento de alguns patógenos. Na cultura do arroz, por exemplo, são conhecidos aproximadamente 100 genes R para brusone (Magnaporthe oryzae), os quais têm sido amplamente usados em programas de melhoramento (Singh et al. 2015). Na cultura da soja para a ferrugem asiática (P. pachyrhizi) são conhecidos alguns genes R dominantes e independentes, sendo que em 2012 foi relatado o gene Rpp6, o qual confere resistência total à ferrugem (Li et al. 2012). Para o trigo existe
62 DESENVOLVIMENTO SUSTENTÁVEL
o gene Stb que atua na resistência contra a mancha salpicada (Zymospetoria tritici) (Rosielle e Brown 1979) e o gene TaWRKY45 contra a giberela (Fusarium graminearum) (Bahrini et al. 2011). Apesar de muitos casos de sucesso, o uso da resistência não é possível em todas as culturas ou para todas as doenças.
A nutrição de plantas exerce um importante papel na regulação do metabolismo vegetal, mas também pode aumentar ou diminuir a resistência das plantas às pragas e doenças. Segundo a Teoria da Trofobiose estabelecida por Francis Chaboussou na década 70, a sanidade dos vegetais é dependente do equilíbrio de seus nutrientes, onde plantas com nutrição adequada são mais resistentes ao ataque de pragas e doenças. Apesar do grande número de informações disponíveis sobre o manejo de doenças pelo uso da nutrição mineral, existem poucos trabalhos que demostram sua eficiência na redução no uso de produtos químicos, aliado ao aumento da produtividade dos cultivos. A eficiência da nutrição mineral devese basicamente a alterações nas respostas de defesa da planta ao ataque de patógenos e insetos. As respostas seriam o resultado de uma maior barreira física, evitando a penetração das hifas, tais como, lignificação e/ou acúmulo de silício na camada de células epidérmicas; melhor controle da permeabilidade da membrana citoplasmática, evitando assim a saída de açúcares e aminoácidos para o apoplasto, ou espaço intercelular; e formação de compostos fenólicos, com distintas propriedades fungistáticas (Zambolim e Ventura 1993). Grande parte dos elementos minerais requeridos para o crescimento das plantas tem efeitos sobre a resistência a pragas e doenças, sendo o nitrogênio (N), o fósforo (P) e o potássio (K) os mais relatados. O N é adicionado ao solo na forma de amônio (NH4+) e/ou nitrato (NO3-). Plantas crescidas em solos fertilizados com nitrato apresentam sintomas mais severos de doenças como a sarna da batata (Streptomyces scabies), mal do pé do trigo (Gaeumannomyces graminis) e a murcha causada por Verticillium spp.. Por outro lado, doenças vasculares causadas por Fusarium oxysporum, hérnia das crucíferas (Plasmodiophora brassicae) e a podridão do colo (Sclerotium rolfsii) são mais severas quando em solos fertilizados com nitrogênio na forma amoniacal (Fry 1982).
Quando a disponibilidade de N na planta é alta, há uma maior demanda de carbono da fotossíntese via ciclo de Krebs, ficando, assim, comprometida a síntese dos metabólitos secundários. Por outro lado, em condições limítrofes, ocorre a formação de compostos fenólicos e alcaloides, que atuam diretamente nas respostas de defesa da planta. Além disso, o excesso de N favorece um maior crescimento da planta, o que aumenta a predisposição ao ataque de insetos afídeos (Barros et al. 2007).
O P está envolvido na formação de uma série de compostos orgânicos e em processos metabólicos de vital importância para a planta, contudo, sua ação na resistência às doenças é muito variável (Zambolim e Ventura 1993). Aplicações de superfosfato podem aumentar a síntese de proteínas e a atividade celular dos tecidos vegetais, proporcionando uma maior resistência das
63 MANEJO ECOLÓGICO
plantas ao ataque de nematoides (Novaretti 2000). Além disso, por acelerar a maturação dos tecidos, doses crescentes de P têm sido importantes na redução do ataque de alguns patógenos necrotróficos, como a cercosporiose do café (Cercospora coffeicola). Apesar dos efeitos benéficos, altos níveis de P, também podem aumentar a severidade de alguns patógenos biotróficos, como é o caso da ferrugem polisora do milho (Puccinia polysora) (Colombo et al. 2014). No caso de insetos, a adubação fosfatada favorece o aumento populacional de pragas na cultura da soja (Cardoso et al. 2002).
O K é outro elemento que apresenta resultados promissores na redução da incidência de pragas e doenças. A deficiência deste elemento pode ocasionar acúmulo de aminoácidos solúveis necessários para o crescimento dos patógenos. Como são moléculas simples, também são altamente desejadas pelos afídeos. O teor de glutamina, por exemplo, é particularmente alto nas plantas deficientes em K e favorece a germinação de esporos, como os de M. oryzae, agente causal da brusone do arroz (M. oryzae). Além disso, a perda de turgor ocasionada pela deficiência de K pode favorecer a penetração dos patógenos e os danos por insetos (Yamada 2004).
2.1.3 Desenho e manejo do agroecossistema
O desenho e o manejo do agroecossistema desempenha um papel importante no controle de pragas e doenças. Por meio da diversificação, incorporam-se aos sistemas agrícolas processos ecológicos como a auto-regulação das populações, ciclagem de nutrientes, controle do microclima local, regulação dos processos hídricos e da abundância dos organismos indesejáveis, resultando em maior estabilidade, resistência a perturbações e capacidade de resiliência do sistema (Altieri et al. 2003).
Em monoculturas, herbívoros apresentam maior taxa de colonização, maior potencial reprodutivo, permanecem mais tempo na cultura e tem maior facilidade no encontro de hospedeiros. Esses fatores dificultam a ação de inimigos naturais, ocorrendo constante intervenção por parte do agricultor (Altieri et al. 2003). Nesse sentido, a literatura mostra que é possível estabilizar comunidades de insetos em agroecossistemas desenhados por meio de uma resistência associativa. Isso é possível graças ao emprego de plantas selecionadas, onde o policultivo pode criar microclimas complexos reduzindo o ataque de insetos. Esse efeito é observado no consórcio de diferentes espécies vegetais, onde há uma redução da visibilidade das plantas e desenvolvimento de populações de inimigos naturais.
É possível também a manipulação de insetos por meio do manejo de plantas invasoras e/ou armadilhas. Embora estas plantas sejam hospedeiras de insetos praga e patógenos, sua ocorrência pode favorecer a presença de parasitoides e predadores por meio da disponibilidade de hospedeiro-presas, pólen ou néctar, além de criar um micro habitat que não está disponível em algumas monoculturas (van Emden 1965).
64 DESENVOLVIMENTO SUSTENTÁVEL
Assim, dentro do desenho e manejo dos agroecossistemas, são passíveis de ser alterados no tempo e no espaço, sequências e associações de culturas, diversidade da vegetação espontânea, diversidade genética dentro de cada espécie, etc (Altieri et al. 2003).
2.1.4 Controle biológico
O centro do manejo ecológico de doenças está no controle biológico (CB). Nos últimos anos, este tipo de controle vem ganhando cada vez mais destaque devido à busca por uma produção agrícola mais sustentável (Parra et al. 2002).
O CB de doenças de plantas refere-se à destruição parcial ou total de populações de patógenos por outros organismos que ocorrem habitualmente na natureza (Agrios 2005), e podem ser selecionados e reaplicados em concentrações mais altas e em momentos oportunos para exercer sua ação antagônica. As populações naturais de microrganismos benéficos também podem ser aprimoradas através do manejo adequado das culturas (Mondino e Vero 2006). Já o CB de pragas é utilizado por meio da introdução, conservação e multiplicação de agentes de controle, sendo caracterizados respectivamente como controle biológico clássico, natural e aplicado. O CB clássico (introdução) consiste na importação, liberação e colonização por parasitoides ou predadores. Já o CB natural (conservação) está ligado a populações de inimigos naturais que ocorrem naturalmente e devem ser preservadas por meio de estratégias que tornem possível a manutenção desses organismos benéficos nas áreas de cultivo. O CB aplicado (multiplicação) tem por objetivo a produção massal de inimigos naturais em biofábricas e posterior liberação de milhares parasitoides ou predadores no ambiente. Essa estratégia tem por objetivo a redução rápida da praga por meio da saturação do ambiente com organismos antagônicos, o que exerce o mesmo efeito da aplicação de um inseticida convencional. Os micro-organismos antagonistas desempenham um papel muito importante no equilíbrio populacional de organismos patogênicos. Dessa forma, o conhecimento dos mecanismos envolvidos no CB é de fundamental importância para aumentar as vantagens competitivas no ambiente. Os principais mecanismos das interações antagonistas entre microrganismos são a antibiose, a competição e o parasitismo (Johnson et al. 2010). Nesse sistema, um mesmo organismo pode interagir com seus pares através de mecanismos distintos, ou seja, pode evoluír e funcionar em um contexto multitrófico. Por exemplo, microrganismos que promovem o controle de doenças por meio de antibiose são capazes de secretar metabólitos capazes de inibir ou impedir o desenvolvimento de uma população de outra espécie. Na competição espera-se que o agente controlador seja capaz de crescer de maneira mais eficiente que o patógeno no local de infecção. Refere-se a uma luta entre duas populações de nichos semelhantes para obter um recurso indispensável, como nutriente, água, luz, espaço, oxigênio, que no habitat se encontra em quantidade insufi-
65 MANEJO ECOLÓGICO
ciente para suprir a demanda biológica (Bettiol e Morandi 2009). Parasitismo ou hiperparasitismo é a relação nutricional entre dois organismos em que um deles, o parasita, obtém seu alimento à custa do outro, o hospedeiro.
Além da ação de insetos predadores e parasitoides, o CB de pragas conta com a ação de micro-organismos que tem o potencial de causar epizootias naturais que são responsáveis por dizimar populações de insetos. Esse ramo é chamado de controle microbiano e visa a manutenção da população das pragas abaixo do nível de controle (Gallo et al. 2002). Entre os micro-organismos mais empregados estão os fungos, bactérias e vírus, mas existem estudos com protozoários, nematoides, rickétsias e mollicutes associados ao controle de insetos. Os fungos entomopatogênicos ocupam lugar de destaque por serem virulentos a insetos e especializados na penetração via tegumento, o que os coloca em vantagem sobre outros grupos de patógenos que só entram por via oral (Alves 1998).
Apesar do CB ser um método muito eficiente, ainda existem poucos produtos de uso comercial no Brasil. Isso ocorre porque o efeito de um produto biológico nem sempre pode ser reproduzível de forma homogênea em condições de campo, contrastando com o controle químico, no qual quase sempre é possível prever os resultados. Contudo, diversos resultados promissores já foram registrados a campo, e principalmente em condições de cultivo protegido. Nos últimos anos, houve um elevado crescimento no setor de pesquisa e desenvolvimento de produtos para o CB, principalmente porque em alguns casos, como da produção orgânica, esta é a principal ou única forma de controle.
Entre os principais agentes de controle biológico de doenças, podemos citar: bactérias como Bacillus subtilis que atuam no controle de diversas doenças; Pseudomonas putida e P. fluorescens no controle de murchas bacteriana no tomate; Streptomyces spp. no controle de meloidoginoses; Agrobacterium radiobacter no controle da galha da coroa, etc; fungos como Trichoderma spp. eficiente para o controle de patógenos de solo; Gliocladium roseum no controle do mofo cinzento; Talaromyces flavus no controle de Verticillium spp.; Pythium oligandrum; Ampelomyces quisqualis, entre outros.
Entre os principais agentes de controle biológico de pragas, podemos citar: Baculovirus no controle da lagarta da soja; Beauveria bassiana no controle de ácaros e broca do café; Metarhizium anisopliae para trips, cigarrinhas e cupins; Bacillus thuringiensis para diversas espécies de lagartas; Lecanicillium spp. no controle da cochonilha verde; Isaria spp. para mosca-branca, etc.
2.1.5 Controle seletivo
O controle seletivo tem se desenvolvido nos últimos anos e tem como objetivo atingir alvos específicos sem causar impacto significativo sobre organismos não alvo. Nesse sentido, práticas culturais e/ou produtos naturais que favoreçam o aumento da população de micro-organismos benéficos ou agentes de CB de fitopatógenos são exemplos.
66 DESENVOLVIMENTO SUSTENTÁVEL
No controle seletivo de insetos, bioinseticidas formulados a partir de micro-organismos podem ser mais agressivos a determinadas pragas alvo do que a seus inimigos naturais (Simões et al. 1998). Atrativos alimentares usados em armadilhas ou iscas envenenadas também exercem efeito sobre algumas espécies, como a mosca-das-frutas. Além dessas estratégias, a confusão sexual vem se destacando cada vez como uma forma de controle seletivo. O sucesso é atribuído ao fato de que feromônios desempenham um importante papel na comunicação entre indivíduos da mesma espécie, como o encontro de machos e fêmeas para cópula (Bento 2001). Esta técnica procura interferir nas trilhas de feromônio liberados pelas fêmeas por meio da saturação do ambiente com feromônio sintético, impedindo que insetos machos encontrem fêmeas para o acasalamento, interrompendo o progresso de novas gerações. O emprego de feromônio sintéticos permite a realização de coletas massais. A coleta massal é um método de controle no qual se utiliza o feromônio sexual emitido pelo inseto para captura e aprisionamento do maior número possível de indivíduos do sexo oposto, de modo que a população seja mantida abaixo do nível de dano econômico (Bento 2001). Entretanto, apesar da eficiência das estratégias de coleta massal e confusão sexual, o uso do feromônio sexual sintético se destaca em ações de monitoramento. O emprego de feromônio sintético possibilita a detecção do inseto logo no início de seu estabelecimento em uma cultura, permitindo ao produtor uma tomada de decisão segura quanto a estratégia de manejo a ser empregada. Devido a sensibilidade deste método de monitoramento, muitos produtores abandonaram o uso de calendários de pulverização, onde pulverizações com inseticidas era muitas vezes realizadas sem observar a ocorrência de pragas na cultura.
2.1.6
Biocidas
Um biocida é considerado como toda substância química ou microrganismo destinado a destruir, tornar inofensivo ou controlar o crescimento de algum organismo nocivo presente na água, no ar e na atmosfera por meios químicos ou biológicos. Geralmente são produtos tipicamente erradicantes, voláteis e altamente tóxicos para todas as formas de vida. A própria palavra biocida significa “mata a vida”. Este termo inclui também organismos não alvos que são atingidos no amplo espectro destes produtos químicos.
Os compostos denominados biocidas estão presentes na elaboração de diversos produtos, desde fungicidas, inseticidas, herbicidas, conservante e sanitizantes. A proteção de plantas por meio de biocidas apresenta características muito atraentes, como a simplicidade e previsibilidade de sucesso. Por outro lado, tem promovido diversos problemas de ordem ambiental, como a contaminação do agroecossistema, resistência de patógenos, de insetos, redução da biodiversidade, entre outros (Bettiol e Morandi 2009).
Os inseticidas e os fungicidas ainda são os mais empregados no manejo de pragas e doenças de importância agrícola. Os inseticidas são considerados
67 MANEJO ECOLÓGICO
os mais nocivos para o agroecossistema. Estes produtos atuam sobre insetos através do bloqueio de processos fisiológicos ou bioquímicos (Gallo et al. 2002) e são classificados segundo seu modo de ação. Entretanto, independente do modo de ação, seu uso deve ser baseado em critérios, que são obtidos por meio de estratégias de monitoramento. Já os fungicidas são responsáveis por controlar satisfatoriamente muitas doenças onde as práticas culturais muitas vezes não proporcionam um controle adequado. Uma boa parte destes produtos precisam ser aplicados antes que a doença ocorra, ou no momento em que os primeiros sintomas são visíveis, para serem eficazes. Nesse sentido, muitos agricultores acabam por aplicar altas quantidades de fungicidas de forma desnecessária.
Atualmente existem diversos biocidas de origem natural, provenientes de micro-organismos, extratos de plantas medicinais, óleos essenciais, entre outros, que são de baixa toxicidade, possuem menor ocorrência de resistência e não prejudicam o ambiente pois são facilmente degradados. Entre os inseticidas, podemos citar alguns rotenóides e alcalóides provenientes de espécies vegetais. Entre os fungicidas, os que merecem maior destaques são os óleos essenciais, sendo que cerca de 60% possuem propriedades antifúngicas e 35% exibem também propriedades antibacterianas (Maia et al. 2015).
O Brasil não possui uma legislação pertinente e específica para produtos biocidas, nem ao menos uma definição legal presente em documentos regulatórios. Muitos biocidas são regulamentados somente pela Lei de Agrotóxicos (Lei nº 7802/89). O que nos deixa em desvantagem em relação a outros países desenvolvidos. Alguns países da Europa e, mesmo os EUA, são detentores de legislações específicas para os biocidas, o que permite e facilita a produção, distribuição e comercialização do produto com segurança e eficácia. No Brasil, a Agência Nacional de Vigilância Sanitária (ANVISA) aplica subsidiariamente algumas legislações internacionais, como é o caso da utilização de substâncias com ação antimicrobiana utilizada na fabricação de alimentos e afins, mas no caso de produtos de uso agrícola, a regulamentação ainda é muito deficiente. Recentemente, a ANVISA aprovou um novo marco regulatório para o uso dos agrotóxicos no Brasil que visa esclarecer os critérios adotados para avaliação e classificação toxicológica desse tipo de produto. No entanto, tais alterações são contestadas por parte da população, uma vez que muitas não atendem os padrões aceitos internacionalmente.
Nesse contexto, a utilização dos biocidas como forma de manejo, encaminha-se contra muitas das práticas que visam a sustentabilidade do manejo ecológico. Assim, respeitando os princípios desse sistema, o mais interessante seria adotar um modelo onde o topo da pirâmide, representado pelos biocidas seja removido totalmente do sistema até quando produtores e consumidores possam ter segurança com os produtos utilizados.
68 DESENVOLVIMENTO SUSTENTÁVEL
CONSIDERAÇõES FINAIS
Com base no que foi discutido nesse capítulo, é importante enfatizar que a eficiência do manejo ecológico de pragas e doenças na produção agroalimentar requer uma abordagem multidisciplinar, ou seja, precisa levar em consideração questões econômicas, sociais e ecológicas do agroecossistema. Este modelo, não visa somente o aumento da produtividade, mas sim, uma melhora na qualidade dos alimentos produzidos sem comprometer o ambiente e os recursos naturais que ali estão inseridos.
Muitos resultados promissores já foram obtidos no manejo ecológico, mas infelizmente o método ainda não é amplamente utilizado pelos agricultores. Mesmo em casos de sucesso, não há uma verdadeira integração dos diferentes métodos, como preconizam os princípios do manejo ecológico. Ademais, a política agrícola brasileira ainda é incipiente no que se refere à expansão de práticas agrícolas sustentáveis. Falta direcionamento para pesquisas nesse sentido. Até pouco atrás, as pesquisas buscavam atender predominantemente o mercado convencional, salvo poucas exceções.
Diversos países, principalmente na Europa, estão entrando na corrida para o desenvolvimento de sistemas de cultivo mais sustentáveis e menos dependentes dos agrotóxicos. Estão priorizando o uso de produtos alternativos que evitem a degradação e o desequilíbrio dos ecossistemas. Os mercados importadores estão cada vez mais exigentes no controle dos resíduos de agrotóxicos nos produtos agrícolas. Assim, uma mudança no entendimento de alguns setores da sociedade e muitas pesquisas ainda são fundamentais para que o manejo ecológico atinja integralmente seu objetivo.
REFERêNCIAS BIBLIOGRÁFICAS
Agrios GN (2005) Plant Pathology, Burlington, MA: Elsevier Academic, 922p.
Altieri MA, Silva EM, Nicholls, CI (2003) O Papel da Biodiversidade no Manejo de Pragas, Editora Holos, 226p.
Alves SB (1998) Controle Microbiano de Insetos, Fealq, 1163p.
Amorim L, Pascholati SF (2011) Ciclo das relações patógeno-hospedeiro. In: Amorim L, Resende JAM, Bergamin Filho A, Manual de Fitopatologia: Princípios e Conceitos, 4ed, Ceres, Piracicaba, pp.59-99.
Barros R. et al. (2007) Efeitos da adubação nitrogenada em algodoeiro sobre a biologia de Aphis gossypii Glover (Hemiptera: Aphididae). Neotropical entomology, 36(5):752-758.
Bajwa WI, Kogan M (2002) Compendium of IPM Definitions (CID)-What is IPM and how is it defined in the Wordwide Literature? IPPC Publication 998, Oregon State University, USA. 19p.
Bahrini I et al. (2011) Characterization of a wheat transcription factor, TaWRKY45, and its effect on Fusarium head blight resistance in transgenic wheat plants, Breeding Science, 61(2):121-129.
69 MANEJO ECOLÓGICO
Bento JMS (2001) Fundamentos do Monitoramento, da coleta massal e do confundimento de insetos-praga.In: Feromônios de Insetos: Biologia, química e emprego no manejo de pragas, Holos, p.135-144.
Bettiol W, Morandi MAB (2009) Biocontrole de doenças de plantas: uso e perspectivas, Jaguariúna: Embrapa Meio Ambiente, 341p.
Brundtland GH et al. (1987) Report of the World Commission on Environment and Development-Our Common future, New York, 300p.
Cardoso AM, Cividanes FJ, Natale W (2002) Influência da adubação fosfatada -potássica na ocorrência de pragas na cultura da soja. Neotropical Entomology, 441-444.
Cavalcanti LS et al. (2015) Indução de resistência em plantas a patógenos e insetos, Piracicaba: FEALQ, 263p.
Chiarappa L (1974) Possibility of supervised plant disease control in pest management systems, FAO Plant Protection Bulletin, 22:65-68.
Colombo GA et al. (2014) Análise dialélica para resistência a ferrugem polissora em milho em diferentes níveis de adubação fosfatada. Bragantia, 73(1):6571.
Dallagnol LJ, Araujo Filho JV (2018) Uma visão geral da resistência genética da planta a microrganismos In: Dallagnol LJ, Resistência genética: de plantas a patógenos, Pelotas, pp.13-47.
Dal Soglio FK, Kubo RR (2016) Desenvolvimento, agricultura e sustentabilidade SEAD/UFRGS, Porto Alegre: Editora da UFRGS, 206p.
de Paula Júnior TJ et al. (2005) Controle alternativo de doenças de plantas-histórico. In: Controle alternativo de pragas e doenças Viçosa, pp.135-162.
Doutt RL, Smith RF (1971) The pesticide syndrome-diagnosis and suggested prophylaxis. In: Biological control, Springer, Boston, pp.3-15.
Embrapa (2019) Vazio sanitário e calendarização da semeadura da soja. https://www.embrapa.br/soja/ferrugem/vaziosanitariocalendarizacaosemeadura. Acesso Setembro de 2019.
FAO (1997) Zonificación agroecológica: guia general. Roma, 1997. 82p.
Fry W (1982) Effect of the physical environment. In: Principles of plant disease management. Academic Press, pp. 83-103.
Gallo D et al. (2002) Entomologia Agrícola. Fundação de Estudos Agrários Luiz de Queiroz, 920p.
Gonçalves AP et al. (2018). Identification of protective isolates of Citrus tristeza virus (CTV) for Citrus sinensis (L.) Osbeck. Summa Phytopathologica, 44(1):17-22.
Gonçalves FP et al. (2010) Postharvest control of brown rot and Rhizopus rot in plums and nectarines using carnauba wax. Postharvest Biology and Technology, 58(3):211-217.
Hoskins WM, AD Borden, AE Michelbacher (1939) Recommendations for a more discriminating use of insecticides. Proc 6th Pac Sci Congr, 5:119-123. Johnson KB (2010) Pathogen refuge: a key to understanding biological control. Annual Review of Phytopathology, 48:141-160.
Kimati H, Bergamin Filho A, Amorim L (2011) Princípios gerais de controle. In: Manual de Fitopatologia: Princípios e Conceitos, 4ed, Ceres, Piracicaba, pp.307-323.
70 DESENVOLVIMENTO SUSTENTÁVEL
Lara FM (1991) Princípios de Resistência de Plantas a Insetos, Editora Icone, 336p.
Li S et al. (2012) Identification of a new soybean rust resistance gene in PI 567102B, Theoretical and Applied Genetics, 125(1):133-142.
Maia TF, Donato A, Fraga ME (2015). Atividade antifúngica de óleos essenciais de plantas. Revista Brasileira de Produtos Agroindustriais, 17(1):105-116.
McDonald BA (2014) Using dynamic diversity to achieve durable disease resistance in agricultural ecosystems, Tropical Plant Pathology, 391:191-196.
Milanez JM et al. (2005) Zoneamento Ecológico de Dilobopterus costalimai Young, Oncometopia facialis Signoret e Acrogonia citrina Marucci e Cavichioli (Hemiptera: Cocadellidae) para SC, Neotropical Entomology, 34:297-302.
Mondino P (2004) Manejo ecológico de fitopatógenos en Uruguay. In: Stadnik MJ e Talamini V (eds), Manejo ecológico de doenças de plantas, Florianópolis, CCA/UFSC, pp.159-176.
Mondino P, Vero S (2006) Controle biológico de patógenos vegetais, Faculdade de Agronomia, Montevidéu, 158p.
Monteiro LB, Hickel E (2004) Pragas de Importância econômica em fruteiras de caroço. In: Fruteiras de Caroço: Uma Visão Ecológica, pp.223-262.
Novaretti WRT (2000) Efeito do controle de nematóides na adubação fosfatada da cana-de-açúcar, Serie: Boletim Técnico Copersucar, 45p.
NRS (1969) Insect-Pest Management and Control. Washington, DC: The National Academies Press. doi.org/10.17226/18674.
Parra JRP et al. (2002) Controle biológico: Terminologia. In: Controle biológico no Brasil: Parasitoides e Predadores, Editora Manole, pp.1-13.
Paul ND et al. (2005) The use of wavelength-selective plastic cladding materials in horticulture: understanding of crop and fungal responses through the assessment of biological spectral weighting functions. Photochemistry and Photobiology, 81(5):1052-1060.
Primavesi A (1990) Manejo ecológico de pragas e doenças: técnicas alternativas para a produção agropecuária e defesa do meio ambiente, São Paulo: Nobel, 137p.
Rosielle AA, Brown AGP (1979) Inheritance, heritability and breeding behavior of three sources of resistance to Septoria tritici in wheat, Euphytica, 28:385392.
Siah A et al. (2018) Natural agents inducing plant resistance against pests and diseases, In: Natural Antimicrobial Agents. Springer, pp.121-159.
Simões JC, Cruz I, Salgado LO (1998) Seletividade de inseticidas às diferentes fases de desenvolvimento do predador Doru luteipes (Scudder) (Dermaptera: Forficulidae), Anais da Sociedade Entomológica do Brasil, 27:289-294.
Singh RP et al. (2015) Emergence and spread of new races of wheat stem rust fungus: continued threat to food security and prospects of genetic control, Phytopathology, 105:872-884.
Stadnik MJ, Araujo L, Valdebenito-Sanhueza RM (2009) Estratégias alternativas de controle da mancha folia de Glomerella e da sarna da macieira. In: Stadnik MJ, Manejo Integrado de Doenças da Macieira, Florianópolis, UFSC, pp.105-126.
71 MANEJO ECOLÓGICO
Stadnik MJ e Maraschin M (2004) Indução de resistânecia de plantas a fitopatógenos. In: Stadnik MJ e Talamini V (eds), Manejo ecológico de doenças de plantas, Florianópolis, CCA/UFSC, pp.221-244.
Stadnik MJ, Mondino P, Butignol CA (2009) Bases conceituais da proteção do cultivo da macieira, In: Stadnik MJ, Manejo Integrado de Doenças da Macieira, Florianópolis, UFSC, pp.1-20.
Stern VM et al. (1959) The integrated control concept, Hilgardia, 29:81-101.
Thurow LB, Castro CM, Pereira AS (2018) Melhoramento de plantas visando à resistência a patógenos In: Dallagnol LJ, Resistência genética: de plantas a patógenos, Pelotas:Ed UFPel, pp.65-93.
van Bruggen AHC, Finckh MR (2016) Plant diseases and management approaches in organic farming systems. Annual Review of Phytopathology, 54:25-54.
van Emden HF (1965) The role of incultivate land in the biology of crop pests and beneficial insects, Scientific Horticulture, 17:121-136.
Vida JB et al. (2004). Manejo de doenças de plantas em cultivo protegido. Fitopatologia Brasileira, 29(4):355-372.
Whetzel HH (1929) The terminology of plant pathology. Proceedings of the International congress of plant sciences, Ithaca, New York, 1926:1204-1215.
Yamada T (2004) Resistência de plantas as pragas e doenças: pode ser afetada pelo manejo da cultura? Informações Agronômicas, Piracicaba: Potafos, 1(108), pp.1-7.
Zadoks JC, Schein RD (1979) Epidemiology and plant disease management, New York: Oxford University Press, 427p.
Zambolim L, Ventura JA (1993) Resistência a doenças induzida pela nutrição mineral das plantas, Revisão Anual de Patologia de Plantas, Passo Fundo, 1:275-318.
72 DESENVOLVIMENTO SUSTENTÁVEL
CULTIVO DE
PLANTAS
MEDICINAIS: INTEGRAÇÃO DO CONHECIMENTO TRADICIONAL E CIENTÍFICO
Roberta Paulert1 , Patricia da Costa Zonetti1, Juliano Cordeiro1, Carina Kozera2 , Suzana Stefanello2
1 Universidade Federal do Paraná Setor Palotina (UFPR), Departamento de Ciências Agronômicas, Rua Pioneiro, 2153, 85950-000, Palotina-PR, Brasil. E-mail: roberta@ufpr.br
2 Universidade Federal do Paraná Setor Palotina (UFPR), Departamento de Biodiversidade, Rua Pioneiro, 2153, 85950-000, Palotina-PR, Brasil. E-mail: carinakozera@ufpr.br
INTRODUÇÃO
A biodiversidade brasileira apresenta aproximadamente 55.000 espécies de plantas que representam 20 a 22% do total mundial. Devido a esta grande diversidade, o país possui uma fonte promissora de materiais vegetais com atividade farmacológica.
As plantas medicinais são amplamente utilizadas no Brasil. No entanto, várias espécies cultivadas são nativas de outros continentes e foram introduzidas pela colonização. De fato, a maior parte das espécies medicinais cultivadas é exótica (origem Mediterrâneo, Europa, África e Ásia) e domesticada em ecossistemas naturais. Por outro lado, muitas espécies nativas têm estudos químicos e farmacológicos que dão suporte a sua utilização. Outras espécies são empregadas a partir do conhecimento empírico ou tradicional da população.
O uso tradicional é aquele alicerçado no longo histórico de utilização demonstrado em documentação técnico-científica, sem evidências conhecidas ou informadas de risco à saúde do usuário. O conhecimento tradicional é fundamental e, nas últimas décadas, trabalhos de resgate do conhecimento sobre plantas medicinais vêm sendo desenvolvidos, pois servem de base para o desenvolvimento das pesquisas. Em grande parte das instituições de ensino superior, os conhecimentos tradicionais sobre a biodiversidade são resgatados, valorizados e associados a tecnologias para a excelência do conhecimento.
Neste capítulo aborda-se espécies de plantas medicinais que vêm sendo usadas no Brasil, bem como, cuidados para realizar a sua identificação e cultivo dentro de uma perspectica agroecológica.
1. E SPÉCIES VEGETAIS MEDICINAIS
Por definição, planta medicinal é uma espécie vegetal, cultivada ou não, utilizada com propósitos terapêuticos. As plantas medicinais frescas são
Stadnik MJ, Velho AC, Zorrilla SE (eds.) Desenvolvimento Sustentável na Produção Agroalimentar
73
5
aquelas usadas logo após a colheita/coleta sem passar por qualquer processo de secagem. O plantio e o consumo de plantas medicinais, incluindo as aromáticas e condimentares, sejam elas nativas ou exóticas, vêm crescendo a cada ano. A Tabela 1 descreve algumas espécies medicinais nativas ou exóticas que são cultivadas e utilizadas no Brasil.
Tabela 1. Espécies medicinais nativas e/ou exóticas cultivadas e utilizadas no Brasil.
Nome popular Nome científico
Alecrim-pimenta
Carqueja
Erva-baleeira
Erva-cidreira
Espécies nativas
Família botânica
Lippia origanoides Kunth Verbenaceae
Baccharis crispa Spreng Asteraceae
Varronia curassavica Jacq. Boraginaceae
Lippia alba (Mill.) N. E. Br. Verbenaceae
Espinheira-santa Monteverdia ilicifolia* Mart. ex Reissek Celastraceae
Guaco
Ginseng-brasileiro
Macela
Ora-pro-nóbis
Alcachofra
Alecrim
Calêndula
Espécies exóticas
Mikania glomerata Spreng. Asteraceae
Pfaffia glomerata (Spreng.) Pedersen Amaranthaceae
Achyrocline satureoiodes (Lam.) DC. Asteraceae
Peresekia aculeata Mill. Cactaceae
Cynara scolymus L. Asteraceae
Rosmarinus officinalis L. Lamiaceae
Calendula officinalis L. Asteraceae
Camomila Chamomilla recutita (L.) Rauschert Asteraceae
Capim-limão Cymbopogon citratus (DC.) Stapf Poaceae
Funcho
Gengibre
Foeniculum vulgare Mill. Apiaceae
Zingiber officinalis Roscoe Zingiberaceae
Melissa Melissa officinalis L. Lamiaceae
Informações de acordo com os bancos de dados do Missouri Botanical Garden (2012) e do Jardim Botânico do Rio de Janeiro, através do site Flora do Brasil (2010).
*Nova denominação do gênero Maytenus conforme proposto por Biral et al. (2017).
As plantas ou suas partes com fins medicinais, que contenham as substâncias responsáveis pela ação terapêutica, após processos de coleta/colheita e secagem (denominadas de chás medicinais), são preparadas por meio de infusão, decocção ou maceração em água pelo consumidor; podendo estar na forma íntegra, rasurada, triturada ou pulverizada (Fig. 1).
Os produtos naturais obtidos das plantas medicinais também podem ser usados como alimentos, corantes, condimentos, aromatizantes, flavorizantes, em cosméticos ou como conservantes. Além disso, diversas plantas me-
74 DESENVOLVIMENTO SUSTENTÁVEL
dicinais podem ser produzidas como ornamentais devido a beleza das suas folhas e flores. Nas últimas décadas, observou-se o resgate pelas terapias complementares à medicina moderna e a valorização dos produtos naturais. No Brasil, estima-se que o mercado de plantas medicinas, aromáticas e condimentares envolva altos valores (devido ao maior valor agregado), despertando assim o interesse de um número cada vez maior de produtores rurais. Aliado as condições do clima e das características do solo, que são favoráveis, existe um grande potencial para a produção econômica destas espécies medicinais (nativas ou exóticas) com qualidade.




Figura 1. Os chás medicinais (A) macela (Achyrocline satureioides (Lam.) DC.); (B) tarumã (Vitex taruma Mart.); (C) laranja-amarga (Citrus aurantifolia (Christm.) Swingle) e (D) hibisco ou groselha (Hibiscus sabdariffa L.) podem estar na forma íntegra, rasurada ou triturada e são preparados geralmente por meio de infusão pelo consumidor.
2. CULTIVO AGROECOLÓGICO
A agricultura sustentável caracteriza-se na forma de produção que deve ocorrer de forma integrada com a compreensão dos processos que regem os agroecossistemas e que forneça rendimentos sustentados a longo prazo, através do uso de tecnologias de manejo ecológico. Os cultivos sustentáveis devem primar pela menor dependência de insumos externos, uso de recursos renováveis disponíveis localmente, adequação às condições ambientais encontradas, manutenção a longo prazo da capacidade produtiva, preservação da diversidade biológica e cultural, bem como do conhecimento e da cultura da população local, entre outros.
A concretização deste tipo de agricultura requer o desenvolvimento e aplicação de um conjunto de diferentes técnicas, tais como: rotação e consórcio de culturas, culturas em faixas de rotação e em faixas de retenção, adubação verde, plantas de cobertura e cobertura morta (mulch), cultivo em contorno ou plantio em nível, terraceamento, cultivo mínimo, plantio direto, entre outros.
As técnicas e práticas que visam a sustentabilidade dos cultivos agrícolas podem ser aplicadas em regiões com condições ambientais
75 CULTIVO DE PLANTAS MEDICINAIS
B C D
A
distintas, pelos mais diferentes públicos e em todos os tipos de cultivos como frutíferas, grãos, culturas perenes, hortaliças, flores e plantas medicinais. Devido ao diferencial relacionado ao tipo de utilização das plantas medicinais, aromáticas e condimentares, o uso de técnicas sustentáveis devem ser critérios indispensáveis e coadjuvantes na sua forma de cultivo e produção.
Tanto para o cultivo comercial quanto para a horta medicinal, o cultivo de qualidade das espécies tem importância fundamental, evitando assim o extrativismo predatório. É necessário ter garantias da identidade botânica e da boa qualidade fitossanitária do material de propagação.
3. CUIDADOS COM A IDENTIFICAÇÃO DAS ESPÉCIES DE PLANTAS MEDICINAIS
É importante identificar corretamente a espécie medicinal que se pretende utilizar. Isso porque na natureza há plantas que possuem morfologia semelhante, mas que correspondem a distintas espécies, inclusive com substâncias químicas diferenciadas e com ações diversas no organismo, podendo causar reações adversas e, até mesmo, problemas à saúde.
Como exemplos de plantas que possuem semelhança física, mas constituição química diferenciada, citam-se o capim-limão (Cymbopogon citratus (DC.) Stapf) e a citronela (Cymbopogon winterianus Jowitt ex Bor), o boldo (Plectranthus barbatus Andr.) e o malvarisco (Plectranthus amboinicus (Lour.) Spreng.), a melissa (Melissa officinalis L.) e o hortelã (Mentha spp.). A forma de crescimento e o formato das suas folhas são parecidas, porém indicadas para finalidades diferentes. Aspectos como o cheiro das folhas amassadas e a textura das folhas auxiliam na identificação das espécies, porém não são suficientes. É necessário certificar-se quanto à identificação botânica, ou seja, o seu nome científico, que é universal e igual em todas as partes do mundo. Este aspecto é imprescindível para o cultivo, verificando a planta correta que será utilizada para o cultivo, evitando o uso de outras que tenham, coincidentemente, o mesmo nome popular daquela que se pretende utilizar. Além disso, se for possível ainda, o ideal é confirmar a identificação da planta por meio de imagens ou figuras que a ilustrem em material científico.
Outro aspecto que deve ser considerado é a fonte de consulta para o uso das plantas medicinais. Há muita informação de conhecimento popular que não tem embasamento científico e há risco de uso inapropriado de alguma espécie de planta. O ideal é que a consulta seja realizada a partir de livros ou informativos relacionados à área técnica, que contenham informações baseadas em pesquisas ou em artigos científicos; em publicações como folders ou manuais elaborados por órgãos públicos de saúde, como a Agência Nacional de Vigilância Sanitária (ANVISA), ou por instituições de apoio técnico como a Empresa Brasileira de Pesquisa Agropecuária (EMBRAPA), o Instituto Paranaense de Assistência Técnica e Extensão Rural (EMATER), Instituto Agronômico do Paraná (IAPAR), ITAIPU Binacional ou ainda por instituições de pesquisas,
76 DESENVOLVIMENTO SUSTENTÁVEL
como universidades. Muitas vezes estes materiais estão disponíveis online, facilitando o acesso ao conhecimento. No entanto, a identificação botânica segura, com o nome correto, poderá ser realizada por botânicos, agrônomos, engenheiro florestal ou profissionais com vasta experiência na área. O produtor pode coletar um ramo florido e encaminhar aos profissionais para análise. Apenas com a identificação correta da espécie com nome científico e assegurado a identidade botânica, o início do cultivo poderá iniciar-se. A seguir são apresentadas algumas orientações gerais para melhor compreensão dos cuidados durante o cultivo das plantas medicinais.
4. ORIENTAÇõES PARA INICIAR O CULTIVO DE PLANTAS MEDICINAIS
Apesar da demanda crescente e do maior valor agregado das plantas medicinais, aromáticas e condimentares, o mercado é instável, sofrendo com variações/flutuações de preço e de oferta de matérias-primas. Assim, na escolha das espécies, é vantajoso optar pelas plantas que apresentem propriedades terapêuticas seguras e eficazes como alecrim, manjericão, alcachofra, hortelã, sálvia, melissa, calêndula, maracujá, capim-limão, camomila, guaco, espinheira-santa, entre outras. O mercado voltado à comercialização pode ser nacional ou internacional e os possíveis compradores podem ser: empresas fabricantes de essências/aromas, indústrias alimentícias, fábricas de laticínios, ervanários e feiras, intermediários e atacadistas, laboratórios farmacêuticos. Existem inúmeros fatores que influenciam a quantidade do conteúdo total e/ou a proporção relativa dos metabólitos secundários e que devem ser observados como normas para a coleta adequada. Apesar do controle genético, o acúmulo dos metabólitos secundários sofre variação diária, sazonal e entre espécies ou plantas, ou seja, existe uma ligação muito estreita entre as plantas e as condições ambientais (Gobbo-Neto e Lopes 2007).
A produção de compostos fenólicos (como flavonoides e taninos) e óleos essenciais é aumentada pela exposição da radiação solar e diminuída pelo fornecimento abundante de nitrogênio. De uma forma geral, verifica-se que o estresse nutricional resulta em aumento nas concentrações de metabólitos secundários. O estresse hídrico frequentemente leva a um aumento na produção de vários tipos de metabólitos (Gobbo-Neto e Lopes 2007), como no caso do alecrim e do capim-limão.
A adaptação das espécies vegetais às mudanças ambientais pode resultar em alterações anatômicas e morfológicas, como por exemplo no aumento do número de tricomas nas folhas, onde são armazenados os óleos essenciais (Martins et al. 2008). Portanto, os produtores devem seguir as recomendações técnicas previstas para cada espécie. O cultivo necessita da disponibilidade maior de mão-de-obra qualificada em todas as fases de produção e beneficiamento, quando comparado a outras culturas, mesmo que as espécies cultivadas sejam mais rústicas como a calêndula.
77 CULTIVO DE PLANTAS MEDICINAIS
A colheita do material vegetal deve ser feita com tempo seco. Não se recomenda a colheita logo após um período de chuvas prolongado, pois a quantidade de metabólitos secundários pode diminuir em função do aumento da umidade da planta (Corrêa Junior e Scheffer 2013). Durante a colheita e o transporte, o material deve ser protegido do sol para evitar o processo de degradação. Após serem colhidas, as plantas devem ser transportadas rapidamente para o local de beneficiamento e secagem.
O beneficiamento das plantas medicinais varia de acordo com a forma de comercialização. A secagem deve ser feita no mesmo dia da colheita e é um método de conservação eficaz quando bem conduzido. Seu objetivo é aumentar a estabilidade química porque reduz a atividade enzimática catalítica e o desenvolvimento de microrganismos. A secagem promove a concentração dos princípios ativos, permitindo a conservação das plantas por mais tempo; além de facilitar o manuseio e a comercialização.
A germinação de algumas sementes é influenciada pela luz e pelo calor. A camomila e a melissa, por exemplo, exigem pouca terra sobre as sementes, pois necessitam de luz para germinar (Corrêa Júnior et al. 2013).
O material de propagação (estacas, sementes e mudas) deve estar isento de pragas e doenças. Como por exemplo, no caso do gengibre que deve ter mudas de alta qualidade, assegurando características genéticas de interesse e aspectos fitossanitários, visto que a disseminação de nematoides pode estar associada com rizomas contaminados.
A importância da certificação da identidade botânica das espécies a serem cultivadas já foi descrita anteriormente e quando não há material de propagação disponível para a compra, o próprio produtor pode fazer através de coletas. O material vegetal deve ser coletado de plantas matrizes com boa qualidade: características produtivas de interesse e que apresentem bom estado fitossanitário, livres de pragas e doenças.
5. FORMAS DE PROPAGAÇÃO
As plantas medicinais, assim como outras, podem ser multiplicadas por meio de sementes ou vegetativamente.
5.1 Propagação por sementes ou propagação sexuada
As sementes devem ser coletadas quando estiverem completamente formadas e secas. Caso a espécie apresente frutos deiscentes (que se abrem quando maduros), as sementes devem ser coletadas anteriormente a este processo. Na maioria das espécies, o armazenamento das sementes pode ser feito em sacos de papel em câmara fria (Corrêa Junior e Scheffer 2013).
Para a semeadura, as sementes devem ser selecionadas principalmente levando em consideração a sua sanidade (ou seja, sua saúde, que é observada visualmente). Se as sementes estiverem com aspecto diferente do normal,
78 DESENVOLVIMENTO SUSTENTÁVEL
devem ser descartadas. A semeadura pode ser realizada em sementeira, normalmente constituída de um canteiro situado em local sem sombreamento ou, em recipientes diversos como vasos, sacos plásticos, copos plásticos, vasilhames recicláveis como garrafas pet cortadas, etc. Nestes casos, para escoar a água, é importante fazer alguns furos na parte inferior dos recipientes. O substrato da sementeira deve ser leve e ao mesmo tempo fértil.
Dentre os substratos que podem ser utilizados na produção de plantas medicinais estão, além do solo, a areia misturada com esterco ou substrato comercial. Caso seja utilizado esterco, este deve estar bem decomposto (curtido).
São exemplos de plantas medicinais que podem ser propagadas por sementes: alcachofra (Cynara scolymus L.), espinheira-santa (Monteverdia ilicifolia Mart. ex Reissek), calêndula (Calendula officinalis L.), sálvia (Salvia officinalis L.), capuchinha (Tropaeolum majus L.), camomila (Chamomilla recutita (L.) Rauschert), funcho (Foeniculum vugare Mill.) (Fig. 2).

Figura 2. Sementes de plantas medicinais: (A) alcachofra (Cynara scolymus L.), (B) espinheira-santa (Monteverdia ilicifolia Mart. ex Reissek), (C) calêndula (Calendula officinalis L.), (D) sálvia (Salvia officinalis L.) e (E) capuchinha (Tropaeolum majus L.).
5.2 Propagação vegetativa
É realizada por meio de estruturas vegetais com capacidade de crescer e dar origem a um novo indivíduo, preservando-se algumas gemas e nós da planta. O substrato para propagação vegetativa deve ser preparado de forma a sustentar as estacas, rizomas, rebentos, ou outra forma de propagação durante o período de enraizamento. Solos argilosos dificultam a passagem da água e, neste caso, devem ser misturados com areia na proporção de 3:1, ou deve ser utilizado terra, areia e substrato orgânico na proporção 1:1:1 criando com isso condições adequadas de crescimento do vegetal.
A propagação por estaquia consiste em destacar pequenas porções da planta matriz, tais como, ramos, folhas ou raízes e colocá-las em local adequado para que haja formação do sistema radicular e desenvolvimento da parte aérea. Recomenda-se enterrar no máximo 1/3 da estaca no substrato. As estacas devem ser coletadas nas horas mais frescas do dia (de preferência ao ama-
79 CULTIVO DE PLANTAS MEDICINAIS
A B C D E
nhecer). O corte da estaca caulinar deve ser feito abaixo de um nó, na base. O tamanho destas devem ser preferencialmente de 12 a 15 cm contendo de 3 a 5 gemas (Fig. 3A). Estacas herbáceas podem ser destacadas com a mão, e não cortadas, como o caso da carqueja (Baccharis crispa Spreng). Quando utilizar estacas herbáceas ou semilenhosas deve-se deixar as folhas superiores (em número de duas) e se as mesmas forem grandes, recomenda-se cortá-las ao meio, para diminuir a transpiração. Logo após, as estacas devem ser preparadas diretamente nos canteiros ou em recipientes diversos assim como no caso da semeadura. A propagação por meio de divisão de estruturas especializadas pode ser de várias formas, conforme descrito abaixo:
Rizoma: é um caule subterrâneo que, depois de dividido em porções menores, pode crescer e formar novas plantas como exemplo no gengibre (Zingiber officinale Roscoe) e no açafrão (Curcuma longa L.) (Fig. 3B).
Touceiras: também podem ser chamadas de céspedes. São um conjunto de plantas que nascem muito próximas formando um tufo ou moita; como por exemplo no capim-limão (Cymbopogon citratus (DC.) Stapf) (Fig. 3C)
Estolão: é um tipo de caule que cresce paralelamente ao substrato e pode enraizar e formar novas plantas que permanecem conectadas; caracterizando a propagação de hortelã (Mentha spp.) e da centela asiática (Centella asiatica (L.) Urb.) (Fig. 3D).
Rebentos: são brotações que surgem a partir de plantas adultas e permanecem unidas a ela, como ocorre na babosa (Aloe vera (L.) Burm. F).




Figura 3. Formas de propagação vegetativa de plantas medicinais realizadas por meio de estacas (A) ou por meio de estruturas especializadas denominadas de rizoma (B), touceira (C) ou por estolão (D). Ilustrações por Marion Cordeiro Langner.
6. PRODUÇÃO DE PLANTAS MEDICINAIS NO ESTADO DO PARANÁ
O Paraná mantém a sua relevância na produção agrícola nacional e destaca-se pela produção de milho, laranja, soja, feijão, aveia, centeio e fumo.
80 DESENVOLVIMENTO SUSTENTÁVEL
A
B C D
No entanto, o cultivo de plantas medicinais também é muito significativo. O estado destaca-se na produtividade de cerca de 90% da produção brasileira de plantas medicinais, aromáticas e condimentares liderando o ranking nacional (Corrêa Júnior e Scheffer 2014).
O estado tem destaque nacional devido a tradição no cultivo (há mais de 100 anos) por influência de povos europeus (com o cultivo inicial de camomila como cultura alternativa de inverno), além das condições favoráveis do solo e do clima que colaboram com o desenvolvimento das plantas e aumento da produção. O cultivo também é influenciado beneficamente pelo apoio do Instituto Paranaense de Assistência Técnica e Extensão Rural (EMATER), pelas pesquisas do Instituto Agronômico do Paraná (IAPAR), pelo projeto desenvolvido pela Itaipu Binacional e demais projetos das Universidades; contribuindo para este destaque.
A produção de plantas medicinais, aromáticas e condimentares no Paraná teve início na década de 1980, quando o técnico Cirino Corrêa Júnior, contratado pela EMATER, encontrou pequenas áreas plantadas com camomila nos municípios de Mandirituba e São José dos Pinhais e iniciou um trabalho intenso na região. Depois o incentivo foi ampliado gradativamente para outras áreas do Paraná, voltado ao desenvolvimento do cultivo de plantas medicinais. No mesmo período (em 1981), as pesquisas no Instituto Agronômico do Paraná (IAPAR) começaram progressivamente a reunir uma coleção de espécies como forma de diversificação agrícola e selecionar espécies mais adaptadas às condições do estado.
O programa Plantas Medicinais da Itaipu, desde 2003, tem como objetivo incentivar o uso de plantas medicinais e fitoterápicos nos cuidados com a saúde e fomentar o desenvolvimento sustentável da cadeia produtiva local. As ações são voltadas à estruturação de um arranjo produtivo com estabelecimento de uma relação de aproximação com as partes da cadeia como produtores de plantas medicinais, indústria de insumos farmacêuticos e laboratórios de produção de fitoterápicos. Outra atividade visa facilitar o relacionamento desse setor com os serviços de saúde que estimulam a demanda dos produtos, favorecendo assim o cultivo de plantas medicinais. O trabalho é articulado, desde 2012, envolvendo seis municípios na região que conseguiram captar recursos do Ministério da Saúde para executar projetos com fitoterapia: Foz do Iguaçu, Pato Bragado, Toledo, Vera Cruz do Oeste, São Pedro do Iguaçu e Mundo Novo (MS). A Itaipu mantém hortos de plantas medicinais e o Refúgio Biológico Bela Vista é um espaço de conservação e manutenção de germoplasma. O refúgio contém cerca de 130 espécies e apoia os setores produtivo, educacional e de pesquisa com as mudas produzidas (cerca de 35 mil por ano). Não menos importante, o Programa da Itaipu estabelece parcerias com as universidades da região que desenvolvem projetos de extensão para a comunidade. Eles inserem a temática de plantas medicinais e fitoterapia em suas grades curriculares, desenvolvem pesquisas e também atuam na inovação, prospectando novas plantas e aplicações (Cardozo Junior, 2008).
81 CULTIVO DE PLANTAS MEDICINAIS
Com o intuito de divulgar informações na região Oeste do Paraná sobre plantas medicinais, desde a sua correta identificação até as principais formas de cultivo, de preparo e finalidades terapêuticas, surgiram em 1996, as primeiras atividades de extensão universitária Universidade Federal do Paraná (UFPR) Setor Palotina. Inicialmente as atividades envolveram mulheres de comunidades rurais, depois houve capacitação de profissionais da saúde, das pastorais e agentes comunitários de saúde de Palotina e região. Em 2010, devido à demanda de novos projetos e atividades, foi criado o Programa de Extensão Plantas Medicinais com diversas ações e elaboração de livros, jogos, calendários e outros materiais didáticos acerca do tema plantas medicinais.
Há 23 anos, as atividades na UFPR Setor Palotina buscam divulgar o conhecimento científico em relação ao uso correto das plantas medicinais de uma forma acessível a diferentes grupos. Assim, os grupos passam a utilizar estas plantas com maior frequência e de forma orientada, melhorando a sua saúde. Os conhecimentos das rodas de conversa também são utilizados para pesquisas e disciplinas, contribuindo para a melhoria do ensino superior. De acordo com informações da EMATER, o valor agregado com o cultivo de plantas medicinais é alto e, na comparação com outras culturas, o faturamento por hectare, por exemplo, é sete a dez vezes maior. Em todo o estado do Paraná são cerca de 6 mil ha plantados e cerca de 1,8 mil agricultores familiares que trabalham no cultivo das ervas. São mais de 80 espécies cultivadas em diversas regiões (Fig.4), com destaque para camomila e gengibre.

Figura 4. Cultivo orgânico de gengibre e açafrão no município de Medianeira, no oeste do estado do Paraná.
As espécies mais cultivadas no estado são camomila, gengibre, guaco, capim-limão, maracujá, hortelã, melissa, calêndula, alcachofra, estévia, cavalinha e alecrim. Estas espécies ocupam 92,5% da área cultivada com plantas medicinais, aromáticas e condimentares. Há ainda atividades de coleta de plantas nativas, tais como espinheira-santa, ginseng-brasileiro, guaco, carqueja, chapéu-de-couro, pata-de-vaca, guaçatonga, macela, entre outras.
82 DESENVOLVIMENTO SUSTENTÁVEL
Existem dois grupos de produtores: o primeiro grupo corresponde às pessoas que vendem o excedente como uma forma alternativa de renda e, o segundo, composto por profissionais que têm essa atividade como a principal fonte de renda.
No estado do Paraná também estão sediadas algumas das maiores empresas que fabricam produtos à base de plantas medicinais, aromáticas e condimentares, resultando na demanda regular e crescente ou ainda pequenas unidades de beneficiamento e comércio destes produtos naturais. Os municípios que desempenham papel fundamental na expansão da produção e comercialização das ervas são: Prudentópolis, Imbituva, Santa Maria do Oeste, Campina do Simão, Pinhão, Campo Largo, Pato Bragado, Medianeira, Vera Cruz do Oeste, municípios próximos a Guarapuava e Curitiba, Morretes, Paranaguá, entre outros.
Camomila (Chamomilla recutita (L.) Rauschert): O plantio de camomila chegou ao estado do Paraná há mais de cem anos, trazido por imigrantes alemães, ucranianos e poloneses. Com plantio entre abril e maio, é uma planta anual que morre ao fim do ciclo de florescimento e dispersão das sementes. As flores têm efeito calmante e digestivo, além de ação anti-inflamatória.
A camomila é importante alternativa de renda para o inverno e a colheita das flores inicia-se de 90 a 120 dias após o plantio. É cultivada comercialmente no estado há quarenta anos, com grande expressão pelo valor econômico e número de produtores envolvidos. A produção da camomila envolve cerca de 600 agricultores em um sistema de cooperação entre agricultores familiares e as empresas de beneficiamento. São pequenos produtores, com renda melhor em relação à soja e milho, e uma produção que ocupa área de 3.000 ha no estado e movimenta, em média, R$ 12 a 17 milhões por ano com produção anual de 1.500 a 1.700 t de flores secas.
A produção de camomila destaca-se na economia da região metropolitana de Curitiba, em Mandirituba, que é responsável por quase metade dos 3.000 ha de camomila do Paraná. Os municípios de Prudentópolis, São José dos Pinhais, Araucária e Campo Tenente também concentram um grande número de produtores, que já exportam para a Itália, com o envio de 16 t/ano.
Gengibre (Zingiber officinalis Roscoe): O cultivo do gengibre foi introduzido no Brasil logo após o início da colonização por imigrantes europeus. Entretanto, o cultivo comercial foi iniciado por famílias de japoneses no litoral paranaense há mais de três décadas após a introdução de variedades de rizomas gigantes (Elpo et al. 2008). Além do seu uso culinário, os rizomas e seus subprodutos são utilizados para fins medicinais devido principalmente a sua ação antimicrobiana e anti-inflamatória.
O Estado do Paraná apresenta-se como o maior produtor nacional de gengibre (rizomas in natura) totalizando 1.232 a 3.945 t/ano, em uma área aproximada de 201 ha, distribuída em 26 municípios. Por exemplo, a safra de 2001/2002 contabilizou R$ 3,3 milhões, correspondendo a quase 20% do valor
83 CULTIVO DE PLANTAS MEDICINAIS
bruto da produção das plantas condimentares. O estado de São Paulo também contribui na produção nacional destes rizomas (Negrelle et al. 2005).
A produção paranaense de gengibre está localizada nos municípios de Morretes, Guaraqueçaba, Antonina, Paranaguá e Guaratuba, ocupando uma área aproximada de 100 ha (que já chegou a 194 ha). Morretes é o principal município produtor de gengibre adotando os sistemas tradicional e orgânico com aproximadamente 60% da área cultivada e com 54% do total da produção. Na safra 2005/2006 ofertou 540 t ao mercado interno e externo (representando de 70 a 90% do volume de exportações brasileiras).
A produção é caracterizada por pequenos (área de 0,2 a 0,3 ha), médios e grandes produtores (até no máximo 10 ha). Essas propriedades, em sua maioria, possuem atividade olerícola, englobando a cultura do gengibre e outras hortaliças. São geradoras de empregos, principalmente nas atividades de colheita, preparo e limpeza, classificação e embalagem do produto in natura. O gengibre brasileiro geralmente comercializado no estado destina-se à exportação (70% a 80%), principalmente para Estados Unidos, Reino Unido, Holanda e Canadá. Os principais estados brasileiros exportadores do gengibre in natura são São Paulo, Paraná, e Santa Catarina. Os rizomas que não atingem a qualidade tipo exportação são destinados ao mercado regional. A produção do gengibre mostra-se relevante ao processo de comercialização do rizoma in natura para alimentação ou para o setor industrial, especialmente como matéria-prima para fabricação de bebidas, perfumes e produtos de confeitaria como balas, conservas e geleias. Incluído no grupo das plantas condimentares, o gengibre ocupa o terceiro lugar das plantas medicinais, aromáticas e condimentares mais produzidas no Paraná. No Paraná não há registro de processamento do gengibre em nível industrial, apenas processamento realizado por pequenas indústrias familiares localizadas em Morretes (em torno de 34 no ano de 2003). A produção agrícola do gengibre pode ser considerada uma atividade lucrativa com crescimento gradual e contínua, desde que seja implementado um sistema agroindustrial de manejo e beneficiamento adequado deste produto, sem uso abusivo de insumos agrícolas e sem agrotóxicos. Devem ser observadas tecnologias apropriadas às boas práticas de produção, com ênfase ao combate às pragas e doenças, rotação de cultura e qualidade das mudas. Também, deve-se implementar sistemas de controle higiênico-sanitário da produção como um todo, em especial usar água potável no pós-colheita dos rizomas e das inflorescências.
Ginseng-brasileiro (Pfaffia glomerata (Spreng.) Pedersen): O ginseng -brasileiro é utilizado há séculos pelos índios brasileiros e o cultivo movimenta cerca de R$ 2 milhões por ano. Cerca de 70 agricultores se dedicam ao seu plantio em uma área de 60 ha, com destaque na região de Querência do Norte, no noroeste do Paraná, com terras úmidas nas ilhas e margens do Rio Paraná. Anualmente são exportadas 200 t do ginseng para o Japão. No entanto, a espécie aparece naturalmente nas margens do Rio Paraná e possuía coleta
84 DESENVOLVIMENTO SUSTENTÁVEL
intensiva e predatória de suas raízes que consistia em atear fogo na vegetação, causando dano ambiental. Após alguns dias, o ginseng rebrotava, facilitando sua localização e coleta, para venda das raízes in natura. Assim, no final da década de 1990, surgiu a necessidade de preservar os recursos genéticos e de desenvolvimento de sistemas que permitissem a exploração das espécies de cultivo sustentável. Em 2005, os agricultores da região fundaram uma associação com o objetivo de produzir ginseng orgânico e sustentável começando com 225 mil Kg e movimentação de R$ 675 mil em negócios. Depois, a produção de ginseng-brasileiro atraiu compradores como a França e o Japão, pois este vêm sendo usado como fito-medicamento e suplemento alimentar, devido a sua ação antitumoral, antidiabética e afrodisíaca. Guaco (Mikania glomerata Spreng.): As espécies Mikania glomerata e M. laevigata Sch. Bip. ex Baker, popularmente conhecidas como guaco, apresentam características morfológicas semelhantes, composição química e usos medicinais muito parecidos e são facilmente confundidas. Estas espécies são amplamente utilizadas com evidências pré-clínicas com ação broncodilatadora. Alguns autores sugerem que as espécies M. glomerata e M. laevigata podem ser utilizadas de forma indistinta. Entretanto, novas investigações relacionando essas duas espécies devem ser realizadas, a fim de corroborar e fortalecer a utilização delas como alternativa terapêutica segura, eficaz e de qualidade. No Programa Nacional de Fitoterápicos e Plantas Medicinais, medicamentos fitoterápicos a base de guaco (junto com a espinheira-santa) são fornecidos pelo SUS, por possuírem eficácia comprovada. Portanto, apresenta bom potencial de mercado, o que incentiva a produção. Ambas espécies ocorrem principalmente na Floresta Atlântica do Brasil, amplamente encontradas no estado do Paraná. A cadeia produtiva do guaco na região sul do Paraná é bastante simples e se inicia com a obtenção de ramos e folhas provenientes de coleta seletiva em fragmentos florestais ou através de cultivo tutorado sobre estrutura de arame em áreas específicas. O sistema de exploração do guaco cultivado apresenta um lucro bem superior ao de coleta (44,2 vezes), porém necessita de um investimento 12,6 vezes superior. O guaco coletado contém ramos e folhas de qualidade inferior, pois se desenvolve em ambiente sombreado. Os produtores que cultivam o guaco obtêm uma margem de comercialização de 346,4 % sobre o seu custo de produção. Assim, o seu cultivo é uma alternativa, podendo ser consorciado com espinheira-santa, com boa rentabilidade, gerando trabalho para a população local. Em 1 ha de cultivo, extrai-se em média 0,5 t de folhas em uma única colheita anual, podendo ser seguida de outra colheita no inverno, dependendo das condições. Dentre as plantas medicinais, o guaco cultivado extensivamente em espaldeiras é o que apresenta uma das maiores rentabilidades, com um lucro médio anual de quase R$ 43.000,00. No entanto, antes do cultivo em escala comercial recomenda-se realizar contratos com os compradores, para assegurar a comercialização do produto.
85 CULTIVO DE PLANTAS MEDICINAIS
CONSIDERAÇõES FINAIS
Os conhecimentos tradicionais devem ser resgatados e valorizados, bem como associados às tecnologias para garantir a excelência do conhecimento. A crescente demanda por produtos naturais de qualidade e em quantidade, o resgate das plantas alimentícias não convencionais, a busca de culturas alternativas rentáveis e o estímulo a uma agricultura ecologicamente sustentável merecem atenção especial devido a sua importância socio-econômica. O cultivo diversificado e agroecológico de plantas medicinais, aromáticas e condimentares com materiais de propagação identificados corretamente e com qualidade fitossanitária, seguindo os padrões agronômicos (para melhorar a produtividade e o acúmulo de metabólitos secundários), com cuidados especiais na colheita e na secagem (com temperatura correta) é a melhor forma de garantir as características fitoquímicas e farmacológicas da matéria-prima de qualidade exigidas pelo mercado que se apresenta em expansão.
REFERêNCIAS BIBLIOGRÁFICAS
Altieri MA (1999) Agroecologia Bases científicas para uma agricultura sustentable. Editorial Nordan Comunidad, Montevideo, 338p.
Azevedo CD, Moura MA (2010) Cultivo de plantas medicinais: guia prático. Programa Rio Rural, Niterói, RJ, 19p.
Biral L et al. (2017) Systematics of new world Maytenus (Celastraceae) and a new delimitation of the genus. Systematic Botany, 42(4):680-693.
Brasil. Ministério da Saúde (2018) Informações sistematizadas da relação nacional de plantas medicinais de interesse ao SUS: Mikania glomerata Spreng., Asteraceae - Guaco. Ministério da Saúde, Brasília, 92p
Cardozo Junior EL (2008) Projeto Itaipu de plantas medicinais. In: Congresso Brasileiro de Olericultura, 1-10, 2008. Caderno de Resumos. Maringá: ABH, 2008. http://www.abhorticultura.com.br/eventosx/trabalhos/ev_2/PAL08. pdf. Acesso Setembro 2019.
Chamangasht S et al. (2012) Improving lettuce (Lactuca sativa L.) growth and yield by the application of biofertilizers. Annals of Biological Research, 3(4):1876-1879.
Corrêa Junior C, Scheffer MC (2013) Boas práticas agrícolas (BPAs). Plantas medicinais, aromáticas e condimentares. EMATER, Curitiba, PR, 92p.
Corrêa Júnior C, Scheffer MC, Ming LC (2013) Cultivo agroecológico de plantas medicinais, aromáticas e condimentares, EMATER, Curitiba, PR, 76p.
Corrêa Júnior C, Scheffer MC (2014) As plantas medicinais, aromáticas e condimentares e a agricultura familiar. Horticultura brasileira, 32(3):376-379.
Diaz II, Hunsberger C (2018) Can agroecological coffee be part of a food sovereignty strategy in Puerto Rico?. Geoforum, 97:84-94.
Dutra RC, Campos MM, Santos ARS, Calixto JB (2016) Medicinal plants in Brazil: pharmacological studies, drug Discovery, challenges and perspectives. Pharmacological Research, 112:4-29.
86 DESENVOLVIMENTO SUSTENTÁVEL
Elpo ERS, Negrelle RRB, Rücker NGA (2008) Produção de gengibre no município de Morretes, PR. Scientia Agraria, 9(2): 211-217.
FAO (2018) Agroecological rice production in China: Restoring biological interactions. FAO, Roma, 107p.
Franzon RC, Carpenedo S, Silva JCS (2010) Produção de mudas: principais técnicas utilizadas na propagação de fruteiras. EMBRAPA Cerrados, Planaltina - DF, 56p.
Gasparetto JC, Campos FR, Budel JM, Pontarolo R (2010) Mikania glomerata Spreng. e M. laevigata Sch. Bip. ex Baker, Asteraceae: estudos agronômicos, genéticos, morfoanatômicos, químicos, farmacológicos, toxicológicos e uso nos programs de fitoterapia do Brasil. Revista Brasileira de Farmacognosia, 20(4):627-640.
Gliessman SR et al. (2007) Agroecología: promoviendo una transición hacia la sostenibilidad. Ecosistemas, 16(1):13-23.
Gobbo-Neto L, Lopes NP (2007) Plantas medicinais: fatores de influência no conteúdo de metabólitos secundários. Quimica Nova, 30(2):374-371.
Gomes PA, de Souza MF, Souza Júnior IT, Carvalho Júnior WGO, de Figueiredo LS (2009) Influência do sombreamento na produção de biomassa, óleo essencial e quantidade de tricomas glandulares em cidrão (Lippia citriodora Lam.). Biotemas, 22(4):9-14.
Lameira OA, Pinto JEBP (2008) Plantas medicinais: do cultivo, manipulação e uso à recomendação popular. EMBRAPA, Belém-PA, 264p.
Martins JR, Alvarenga AA, Castro EM, da Silva APO, Oliveira C, Alves E (2008) Anatomia foliar de plantas de alfavaca-cravo cultivadas sob malhas coloridas. Ciência Rural Online, 39(1):82-87.
Matsushita MS et al. (2015) Produção e comercialização do guaco (Mikania laevigata Schultz Bip. Ex Baker) na região sul do estado do Paraná. Revista Brasileira de Plantas Medicinais, 17(3):351-359.
Negrelle RRB, Elpo ERS, Rücker NGA (2005) Análise prospectiva do agronegócio gengibre no estado do Paraná. Horticultura Brasileira, 23(4):1022-1028.
Nodari RO, Guerra MP (2015) A agroecologia: estratégias de pesquisa e valores. Revista Estudos Avançados, 29(83):183-207.
Oliveira Júnior CJF, Gonçalves FS, Couto F, Matajs L (2013) Potencial das espécies nativas na produção de plantas ornamentais e paisagismo agroecológico. Revista Brasileira de Agroecologia, 8(3):190-200.
Paixão, JLF, Humberto D, Oliveira JEZE (2013) Horta orgânica de ervas medicinais: inclusão social na comunidade da Barra em Muriaé/MG - Brasil. Revista Agrogeoambiental, 5(2):19-30.
Paulert R, Pujarra S, de Oliveira FG, Zonetti PC, Ruppelt BM (2014) Utilização popular de plantas medicinais nos clubes de mães de Palotina-PR. Revista Ciência em Extensão, 10(2):55-64.
Ribeiro PGF, Diniz RC (2008) Plantas aromáticas e medicinais. Cultivo e utilização. IAPAR, Londrina - PR, 218p.
Riepe AJ, Moraes PES (2015) Produção agroecológica de hortaliças no assentamento contestado, município da Lapa. Revista Qualidade Emergente, 6:17-30.
87 CULTIVO DE PLANTAS MEDICINAIS
Rodrigues VGS (2004) Cultivo, uso e manipulação de plantas medicinais. Embrapa Rondônia, Porto Velho, 25p.
Ruppelt BM, Kozera C, Zonetti PC, Paulert R, Stefanello S (2015) Plantas medicinais utilizadas na região oeste do Paraná. Editora UFPR, Curitiba - PR, 126p. Silva MLN, Freitas DAF, Cândido BM (2015) Curso da EMATER: manejo do solo em sistemas agroecológicos de produção-parte 2. UFLA. Lavras, 54p.
Trento Filho AJ, Menon MU, Corrêa Júnior C (2010) Caracterização da produção de plantas medicinais, aromáticas e condimentares no território centro-sul do Paraná, Revista Ambiência, 6(3):511-520.
Vasconcelos MAM, Guerreiro CM, Oliveira MA, Fortaleza AP, Filho JJPN, Dias TS (2018) Production system of organic orange and its implications: Study in the SOS site Agroecological, Northeast of Pará. International Journal of Advanced Engineering Research And Science, 5:124-132.
Zonetti PC, Kozera C, Paulert R, Stefanello S, Ruppelt BM (2019) Crianças e plantas medicinais: o conhecimento por meio de atividades lúdicas. Revista Expressa Extensão, 24(1):63-76.
88 DESENVOLVIMENTO SUSTENTÁVEL
PRODUCTOS DEL NORDESTE ARGENTINO DESTINADOS
A INFUSIONES
Marcos G. Maiocchi1 , Elisa M. Petenatti2 , Luis Á. Del Vitto2
1 Universidad Nacional del Nordeste (UNNE), Facultad de Ciencias Exactas y Naturales y Agrimensura, Departamento de Química, Avenida Libertad 5470, (3400) Corrientes, Argentina. E-mail: mgmaiocchi@yahoo.com.ar
2 Universidad Nacional de San Luis (UNSL), Facultad de Química, Bioquímica y Farmacia, Departamento de Farmacia, Ejército de los Andes 950, D5700HHW, San Luis, Argentina. E-mail: empetenatti@gmail.com
INTRODUCCIÓN
La extracción de productos alimenticios, medicinales, aromáticos y/o condimenticios, entre los recursos no madereros obtenidos de áreas boscosas o selváticas, junto a la producción de alimentos vegetales de cultivo, y de carnes por explotación de pasturas naturales o artificiales, asociadas a la producción foresto-industrial, representan las principales actividades agrícolo-ganaderas e industriales en el Nordeste argentino (NEA). El extractivismo, una práctica ancestral actualmente considerada como recurso productivo, no incorpora conceptos de sustentabilidad, al igual que las explotaciones agrícolas y ganaderas de cualquier escala activas al presente en la región. Con ese supuesto, intentamos aportar al análisis de causas y efectos de la explotación de recursos vegetales destinados a infusiones, ya que urge aplicar conceptos y prácticas conservacionistas y tender a la sustentabilidad de la producción.
1. C ONDICIONES y RECURSOS NATURALES DEL NEA
Desde los puntos de vista histórico y geográfico, el NEA es la región integrada por las provincias de Formosa, Chaco, Corrientes y Misiones, incluyendo a menudo el norte de Santa Fe y el NE de Entre Ríos (Argentina 2019). Así entendido, se extiende sobre poco más de 300.000 km2 , entre los 22°30’ y 31°22’ S y los 57°29’ y 63°25’ W, con alrededor de 4 millones de habitantes (INDEC 2012) y presenta rasgos paisajísticos, ambientales, socio-culturales y económicos comunes a las regiones naturales que lo integran. Comprende gran parte de la llanura chaqueña en la Argentina y los diversos ambientes de la Mesopotamia, con planicies, valles fluviales de grandes ríos y sus afluentes, bañados, cuchillas o lomadas, incluso las cerrilladas de
Stadnik MJ, Velho AC, Zorrilla SE (eds.) Desarrollo Sostenible en la Producción Agroalimentaria
89
6
Misiones que alcanzan 800 msnm. Es la cuenca hidrográfica más extensa de Argentina, incluyendo el acuífero Guaraní, y cuenta con cuatro de los ríos más caudalosos del país (Pilcomayo, Bermejo, Paraná y Uruguay) (Popolizio 1970). El clima es subtropical, con mayor índice de continentalidad hacia el oeste (Chaco y Formosa) y temperaturas medias entre 18 y 22°C, y escasos días con heladas. Las lluvias se distribuyen casi uniformemente a lo largo del año en la parte oriental, con 1.000-2.000 mm anuales; por ello el extremo NE de Misiones tiene un balance de agua positivo, mientras en la parte occidental se presenta una estación seca invernal, con precipitaciones entre 800-1.000 mm (Burgos 1970, Burkart et al. 1999). Los suelos fluctúan, desde profundos y muy productivos en las llanuras, hasta lateríticos (rojos) e incluso pedregosos, someros. Corresponden a los órdenes alfisoles, vertisoles, molisoles, oxisoles y ultisoles (Bonfils 1970, Panigatti 2010).
Las formaciones vegetales y biomas predominantes en el NEA son selvas lluviosas, bosques (secos, de coníferas, en galería, palmares), sabanas, matorrales, esteros, embalsados, pajonales, etc. (Cabrera 1976, Ragonese y Castiglioni 1970, Morello 1970) cada uno con su fauna asociada (Ringuelet 1970), y en muchos casos representan las ecorregiones de mayor biodiversidad del país (Burkart et al. 1999, WWF 2019).
2. USO DE LOS RECURSOS A TRAVÉS DEL TIEMPO
Las etnias originarias (Qom, Pilagás, Wichís, Mocovíes y otras agrupaciones menores como Abipones, Chanés, Mataraes, Mocoretás, Mokoits, Nivaclés, Payaguaes, Vilelas, Yofuashas, etc.) fueron influidas notoriamente por la cultura de los Guaraníes, invasores de los siglos XIV y XV, aunque conservaron rasgos particulares (INDEC 2015, Martínez-Crovetto 1970b).
El aprovechamiento de los recursos por los indígenas, variado y amigable con el ambiente, tuvo bajo impacto, al menos hasta la llegada de los conquistadores españoles (Arenas 1981, 1992, 2009, 2012, Martínez 2012, Martínez-Crovetto 1970.a). En la época colonial se establecieron las misiones jesuíticas, cuya influencia perduró más de siglo y medio en la organización de los indígenas en Misiones y Corrientes. Ellos iniciaron la explotación de los montes silvestres de “yerba mate” (Ilex paraguariensis) con la que se producía el entonces afamado “té de los Jesuítas” (Dellacassa 2007, Krapovickas 1970).
El avance en la domesticación de esta especie se truncó con la expulsión de los miembros de la Orden en 1768, empezando un período de decadencia que llevó a la disolución de las reducciones indígenas y al abandono o destrucción de los cultivos, que tuvieron una efímera recuperación con Aimé Bonpland en 1821 (Krapovickas 1970). Porotos, mandioca, zapallos y calabazas, batata y maíz, fueron la base de la alimentación indígena en la región, a los que más tarde se agregaron sorgo, melones y algunos frutales.
90 DESARROLLO SOSTENIBLE
Recién a fines del siglo XIX se produjo una intensa inmigración de colonos europeos a la región, con incremento de la producción agrícola. Contemporáneamente se instalaron también unas pocas empresas latifundistas que explotaron los bosques chaqueños y misioneros hasta la casi extinción de los “quebrachales” y otras especies de maderas nobles (Zarrilli 2004). La ganadería se extendió progresivamente a las praderas y pajonales de Corrientes, Chaco y Formosa, y reemplazó a la explotación forestal en los campos rozados. Superados los problemas de germinación de la semilla, las plantaciones de yerba mate comenzaron a surgir desde 1903 en Misiones (Grondona 1953). La diversificación agrícola vino de la mano de pequeños y medianos productores desde 1930, con el cultivo del algodón en Chaco (Carlino 2009) y un notable incremento de los montes artificiales de yerba mate en Misiones. Más tarde, y con el aumento de parcelas familiares menores de 5 ha, que obligaron a una economía de subsistencia, fueron incorporados cultivos como tabaco, arroz, frutales cítricos, hortalizas, florales, etc. En tanto, las grandes empresas continuaron con una explotación ganadera más tecnificada e implantaron grandes montes forestales (sobre todo monocultivos de pinos y eucaliptos), que transformaron al NEA en la región del país de mayor producción de estas especies.
3. P r OD u CCIONES DE BASE AG r A r IA EN LA ECONOMÍA r EGIONAL
En las últimas décadas, se han sumado a los ya tradicionales cultivos el de la soja, el arroz, el maíz y el girasol, además de la industria forestal. La expansión de cultivos anuales en grandes superficies fue intensa en Chaco, en detrimento del algodón, con el subsiguiente desplazamiento de mano de obra a los centros urbanos. La superficie cultivada con arroz ha experimentado un crecimiento notable en Entre Ríos y sobre todo en Corrientes en los últimos tres decenios. Los cítricos (mayormente naranjos y mandarinos) ocupan hoy en algunas provincias hasta el 20% de la superficie cultivada, y son destinados a consumo en fresco y jugos concentrados. Los cultivos hortícolas (sobre todo pimiento y tomate) se realizan a campo abierto o bajo cubierta; esto último permite la cosecha de primicias o la producción contra-estación (invierno). Entre los cultivos minoritarios figuran caña de azúcar, mandioca, papaya; localmente se encuentra pequeñas explotaciones de ñangapirí, acaí, algarrobo, chañar, mistol, tusca, tuna y ananás silvestres, destinados a la subsistencia y a producción de alimentos en forma artesanal. En general, desde la década del ‘90 la yerba mate y el té han mantenido la superficie y los montos de producción, mientras que el tabaco y el algodón han sufrido disminuciones sensibles. Actualmente cerca del 70% del área cultivada corresponde a capitales intensivos, con propiedades mayores a 1.000 ha, dedicados sobre todo a yerba mate, soja, té, frutas cítricas y bosques artificiales; su alto grado de tecnificación implica el empleo de escasa mano de
91 PRODUCTOS DEL NORDESTE ARGENTINO
obra rural. El gran número de productores minifundistas que ocupan el área restante, con propiedades menores de 50 ha, se dedican mayormente al cultivo de tabaco, algodón, caña de azúcar y hortalizas como maíz dulce, zapallo, mandioca y batata, y a la ganadería de subsistencia (Ramilo 2011). Finalmente, cabe puntualizar que los indicadores socio-económicos de la región la ubican como la segunda más retrasada del país, principalmente debido a que la producción está limitada a pocos cultivos, con escaso crecimiento de la industria de transformación y de la implementación de los servicios asociados, lo que ha llevado a la desocupación y al desplazamiento de mano de obra.
4. USO SUSTENTABLE : UN IMPERATIVO DE NUESTRA ÉPOCA
Las especiales condiciones ecológicas del NEA han permitido el aprovechamiento de gran número de especies de frutales, hortalizas y cereales, como así también plantas medicinales y condimenticias, y forestales nativas y exóticas. A ellas se agrega las producciones locales, sobre todo a partir de plantas medicinales y frutales silvestres o naturalizadas, obtenidas por extractivismo a partir del bosque o cultivadas en pequeña escala.
A causa de la sobreexplotación forestal y ganadera, y a pesar de la sanción de leyes que obligan a las provincias al ordenamiento territorial de los bosques nativos y su manejo sostenible, la mayoría de las selvas y bosques del NEA se han visto disminuidos notoriamente, al igual que la calidad de las pasturas. La degradación está directamente relacionada con la explotación forestal selectiva, el uso del fuego, la difusión de especies invasoras, el incremento de la superficie agrícola, las prácticas agrícolas inapropiadas, el reemplazo de especies nativas con exóticas de rápido crecimiento, y el desplazamiento de las comunidades rurales y aborígenes.
El retorno a las actividades económicas realizadas de manera sustentable exige establecer estrategias para la conservación de la biodiversidad (como se ha establecido en planes oficiales, Argentina 2017), el desarrollo de energías “limpias” y, fundamentalmente, la conciliación de los conocimientos ancestrales con las tecnologías apropiadas o intermedias, particularmente en lo que concierne a la agricultura (Alzate et al. 2019), es decir las que se adaptan a las condiciones ambientales, étnicas, culturales y socioeconómicas de los actores, e incluso las basadas en tecnologías industriales maduras pero mucho más económicas (Schumacher 2010). Para el éxito de estos programas, la mayoría de ellos incluidos en la Agenda 2030 de Naciones Unidas para el Desarrollo Sostenible (Catterberg y Mercado 2017), es fundamental la ejecución concomitante de planes de educación ambiental, la generación de capacidades individuales y comunitarias y de equidad de género, entre otros, que representan a su vez objetivos del Programa de Naciones Unidas para el Desarrollo (PNUD). Importa sobremanera la gestión de otra cantidad de factores que influyen directamente sobre la producción, entre ellos un manejo forestal inte-
92 DESARROLLO SOSTENIBLE
grado y sostenible, que valorice tanto los recursos madereros como no madereros del bosque; medidas efectivas para evitar la erosión y degradación de los suelos; la identificación, recuperación y conservación de semillas de cultivos autóctonos (germoplasma); el restablecimiento poblacional y difusión del uso adecuado de plantas medicinales, curtientes y tintóreas, de las que existe una fundada tradición etnobotánica en la región; el empleo de fibras vegetales y lanas animales para hilados y tejidos artesanales y semi-industriales; el uso de frutas silvestres para la obtención de zumos, jarabes y dulces; etc.
5. PRODUCCIÓN y COMERCIO DE MATERIAL PARA INFUSIONES
La gran diversidad florística del NEA, con numerosas especies de distribución subtropical y tropical, ha influido notoriamente para que tanto los antiguos habitantes como los colonizadores y los actuales pobladores de la región hayan recurrido cotidianamente al consumo de infusiones, decocciones, zumos, jarabes, mermeladas, dulces y otras formas de uso de numerosas plantas alimenticias y/o medicinales. Actualmente una de las actividades más importantes de la región es la producción de alimentos para infusiones. En este trabajo, se abordarán aspectos de la producción y consumo de infusiones, especialmente de la yerba mate, por ser un producto característico de la región y del Cono Sur, desde el punto de vista socio-cultural, y subsidiariamente a té y plantas medicinales y aromáticas. Misiones y el NE de Corrientes tienen la exclusividad nacional en la producción de té y yerba mate, entre los 26° y 28° S. La cuenca tealera está integrada por unos 4.500 productores y la yerbatera por algo más de 11.000 (INYM 2019). En Argentina, se consumen unos 6,9 kg/año de productos destinados a la preparación de infusiones, constituidos por 6 kg de yerba mate, 0,7 kg de café y 0,2 kg de té (Manzoni 2019). Las exportaciones de estos productos para infusiones tuvieron un valor de US$ 192 millones en 2018, con un aumento de 5,3% con respecto a 2017 (8,7% en volumen), totalizando 117.000 t (Ovando 2019). Las exportaciones de té están destinadas principalmente a Estados Unidos y en menor escala a Chile, Polonia, India, Rusia, Alemania, Reino Unido y Perú, entre otros. En 2018, implicaron 73.800 t (INDEC 2019), casi 90% de la producción nacional. El consumo anual per capita equivale a unos 80 saquitos de 2 g. La yerba mate se exporta principalmente a Siria, Chile, Líbano, Francia y Estados Unidos, con 43.000 t en 2018, lo que es 14% de la producción nacional (INYM 2019).
6. P RODUCCIÓN , CONSUMO y PROPIEDADES BIOLÓGICAS DE LA y ERBA MATE
La yerba mate es el producto característico por excelencia del NEA y representa una antigua tradición, dadas las condiciones agroecológicas de la
93 PRODUCTOS DEL NORDESTE ARGENTINO
región. El Código Alimentario Argentino (art. 1193) define como yerba mate al producto que contiene hojas y tallos jóvenes de Ilex paraguariensis St. Hil., desecados, “canchados”, molidos y estacionados (CAA 2019). Otros Reglamentos y Códigos Alimentarios de países vecinos establecen pautas semejantes.
En 2013, fue promulgada la Ley 28871, que declara al mate como “infusión nacional”, para impulsar su difusión a nivel global (Cappelari et al. 2017).
Diversos factores afectan sus características fisicoquímicas, dando lugar a «tipos» de yerba mate que satisfacen a diferentes paladares, convirtiéndose en la bebida analcohólica tradicional del Cono Sur de América (Maiocchi et al. 2018) y extendiéndose las costumbres a otros países, especialmente el Oriente Medio, dado su valor nutricional (vitaminas y minerales) y estimulante (cafeína).
En 2016, la producción mundial de hoja verde de yerba mate alcanzó 1,5 millones de toneladas, siendo Argentina el principal productor mundial con el 54% del total, seguida por Brasil (40%) y Paraguay (6%) (Cadenas de valor yerba mate 2019). La zona productora se limita en la Argentina a Misiones y NE de Corrientes definiéndose diversas regiones (Fig 1).

Figura 1. Zonas productoras de yerba mate en la Argentina (Fuente: INYM 2019).
El complejo yerbatero argentino está organizado en función de múltiples operadores, de los que se encuentran activos 11.228 productores, 191 secaderos, 97 molineros-fraccionadores y 15 fraccionadores, según datos del
94 DESARROLLO SOSTENIBLE
Instituto Nacional de la Yerba Mate (INYM 2019). El efecto multiplicador de esta actividad se observa en las 380 empresas que prestan servicios de cosecha y flete, en los 57 comercializadores, 38 exportadores (INYM 2019). En 2017 el Valor Bruto de Producción (VBP) de la cadena de valor de yerba mate expresó el 0,09% del total nacional. En cuanto a las exportaciones, la yerba mate implica más del 0,15% de las ventas externas del país.
La tabla 1, resume los datos de ingreso de yerba hoja verde, aquella que se cosecha en los yerbales, en forma manual o mecanizada (Cappelari et al. 2017), el movimiento en el mercado interno y el de exportación. Según declara el INYM el movimiento de yerba mate a salida de molino es el indicador más cercano al comportamiento del producto en góndola, ya que incluye tanto el volumen que se envía a los centros de distribución de las firmas yerbateras como las compras efectuadas por los mayoristas, hipermercados y supermercados (INYM 2019).
En referencia al mercado interno (Tabla 1), en 2018 se alcanzó un récord de consumo y para lo que va de 2019 se registra un aumento de 6.400 t respecto de igual periodo. Esto representa la mejor cifra en los últimos 5 años para el ciclo enero-abril (INYM 2019). El 75% del volumen total comercializado de yerba mate está en manos de 12 empresas, mientras que el 25% restante lo comercializan las cooperativas (Nodal 2019).
En los últimos años, las exportaciones han sufrido variaciones, con signos de recuperación para el 2018 según INDEC (2019), alcanzando las 43.000 t, con destino a 41 países. Principalmente a Siria (34.500 t), Chile (4.480 t), Líbano (752 t), Francia (544 t) y Estados Unidos (510 t) (INYM 2019).
Tabla 1. Ingreso de hoja verde de yerba mate, yerba mate mercado interno y externo.
*Incluye yerba mate envasada estampillada / Yerba mate con destino a mercado interno para venta al público sin estampilla (soluble, saquitos, etc.) Fuente (INYM, 2019) ** Incluye yerba mate, molida a granel y envasada (soluble, saquitos, etc.). Fuente (INYM 2019) ***Período de enero a abril. Fuente (INYM, 2019) **** Fuente (INDEC 2019).
Numerosas propiedades de la yerba mate han sido determinadas fehacientemente mediante estudios farmacológicos, de los que destacan la comprobación de los efectos quimioprotectores in vitro de sus extractos (Ramírez-Mares et al. 2004), la activa participación en procesos de inhibición de
95 PRODUCTOS DEL NORDESTE ARGENTINO
Período 2015 2016 2017 2018 2019*** Ingreso hoja verde (miles de t) 810 820 690 809 249 Mercado interno (miles de t) * 250 252 269 262 89 Mercado externo (miles de t) ** 35 29 31 43 10 Exportaciones (millones de uS$) **** 109,0 73,9 80,7 91,6 -
la hiperglicemia (Lunceford y Gugliucci 2005); la actividad antioxidante de los extractos y aceites esenciales (Anesini et al. 2005, Bastos et al. 2006), la inhibición de importantes procesos del estrés oxidativo (Bixby et al. 2005), la acción inhibitoria de oxidación de LDL y la manifestación de efectos antimutagénicos (Bracesco et al. 2011); la actividad cardioprotectora de los extractos de yerba mate (Schinella et al. 2005); etc.
6.1 Análisis químico-nutricionales de formas de consumo Las formas más frecuentes de consumo son cebadura (mate) (Fig. 2), infusión teiforme (mate cocido) o maceración en frío (tereré) y mate cocido con leche. Se la emplea para la preparación de extractos acuosos como infusiones como el “mate cebado” y el “mate cocido”. El mate cocido con leche, endulzado con azúcar refinado constituye un factor importante en la dieta de los escolares, en la franja etaria de 3-13 años, en las escuelas públicas de gran parte de Argentina (Maiocchi et al. 2018).
Cebadura: con esta designación se refiere “al mate cebado”, la forma más popular, antigua y extendida del consumo de la yerba mate en Sudamérica (CRYM 1971). Para la simulación de la cebadura en condiciones de laboratorio se empleó un dispositivo extractor con fines experimentales (Maiocchi et al. 2016) (Fig. 2).
B. MEDIO FILTRANTE
C. CONEXIÓN A VACÍO
D. SALIDA

Figura 2. Sistema experimental de extracción adoptado para cebadura.
Se sometió a extracción 50 g de yerba con 500 ml de agua a 84°C en forma intermitente, en 10 operaciones sucesivas, a intervalos de 2 min, previa colocación de una hoja de papel tisú como medio filtrante (bombilla).
96 DESARROLLO SOSTENIBLE
A. rESErVOrIO
A B C D
Mate cocido y mate cocido con leche: el “mate cocido” (en español) o “chá mate” (en portugués) se preparó adicionando aproximadamente 1 L de agua recién hervida a 20-30 g de yerba mate; la infusión fue filtrada. La infusión en taza fue obtenida adicionando 200 mL de agua de reciente hervor sobre un “saquito” de papel poroso, con aprox. 3 g de producto, endulzado con azúcar refinado de caña. En ambos casos, cuando se adicionó leche de vaca en proporción variable, se obtuvo el llamado “mate cocido con leche”, con notorio incremento del valor nutricional del producto (Maiocchi et al. 2018).
6.1.1 Composición quimica de la yerba mate y sus infusiones
Sobre las infusiones obtenidas, previamente filtradas y acondicionadas se ensayaron diversas técnicas para determinación de extracto acuoso, cafeína, xantinas, ácidos clorogénicos, minerales y vitaminas comparando los datos obtenidos con los reportados por otros autores. Los resultados se expresaron en g/100 g material (%) para el material crudo de yerba mate, en g o mg por porción para el caso de cebadura y mate cocido.
Extracto acuoso: Realizando una simulación de cebadura sobre yerba mate elaborada, Ramallo et al. (1997) obtuvieron 27,02 ± 3,09% de extracto acuoso, mientras que Viera & Sabbatella (2011) comunicaron 16,1 ± 0,5 g para la porción de 50 g de yerba mate. Los resultados obtenidos en yerba mate por Maiocchi et al. (2012) y sus infusiones se presentan en la Tabla 2.
Xantinas: En Ilex la cafeína (1,3,7-trimetilxantina) es el alcaloide que se encuentra con mayor frecuencia entre 1-2% (Heck y Mejía 2007), la teobromina (3,7-dimetilxantina) entre 0,3-0,9% y la teofilina (1,3-dimetilxantina) cerca de 0,1%. Los resultados obtenidos por Maiocchi et al. (2012) se presentan en la Tabla 2.
Ácidos clorogénicos y actividad antioxidante: El ácido clorogénico es el derivado más importante del ácido cinámico presente en frutos, siendo el compuesto fenólico simple predominante (Robards et al. 1999). Presente en el café junto con sus isómeros, en valores comprendidos entre 4-8%, confiere propiedades de amargor y al momento del tostado, influencia el aroma (Hart & Fischer 1984). Entre los compuestos fenólicos presentes en las especies de Ilex, y en la yerba mate en particular (Filip et al. 2001), se destacan los ácidos clorogénicos. Chaves et al. (2002) trabajando con I. paraguariensis concluyeron que el mate cocido supera en actividad antioxidante al té verde y al té negro. En la Tabla 2, se muestran los resultados obtenidos, respecto a la actividad antioxidante, por Maiocchi et al. (2012). La actividad antioxidante (AAO) se expresa en g de equivalentes de ácido clorogénico ya que se incluyen otros biocompuestos con actividad antioxidante.
Minerales: en cuanto a la composición mineral de I. paraguariensis la misma fue reportada por primera vez por Delfino (1990) y Tenorio Sanz y Isasa (1991). Ramallo et al. (1997) determinaron el contenido de Ca, Fe, Mg, K y Na en cebadura. En términos generales, los resultados de estos trabajos
97 PRODUCTOS DEL NORDESTE ARGENTINO
concuerdan con los informados por Maiocchi et al. (2002, 2017), que además realizaron un estudio comparativo de la composición química elemental con la congénere Ilex dumosa.
Vitaminas: participan en los procesos metabólicos de los seres vivos, por su naturaleza proteica son sensibles a los factores de degradación como las altas temperaturas y la exposición a la luz y al oxígeno (Del Valle Argüello y Scipioni 2015).
Tabla 2. Composición de la yerba mate y las infusiones obtenidas por cebadura y mate cocido.
Análisis (unidad)
Actividad antioxidante (g equivalentes de ác. clorogénico)
En la Tabla 3, se presentan los aportes vitamínicos de las porciones de cebadura y mate cocido, información completada con el respectivo valor energético, proteínas, carbohidratos, grasas y fibras (Maiocchi et al. 2017)
6.1.2 Aportes nutricionales del mate cocido y mate cocido con leche
Maiocchi et al. (2018) abordaron el estudio de los aportes del mate cocido y el mate cocido con leche considerando que éstas infusiones constituyen los complementos alimentarios suministrados con más frecuencia a alumnos de entre 3 y 13 años en las escuelas públicas de gran parte de Argentina. Se utilizaron muestras comerciales de mate cocido (MC), de leche de vaca entera (LE) y azúcar refinado (Az) en la preparación del “mate cocido con leche” (MC+LE+Az); todas cumplimentaron los requisitos establecidos por el Código Alimentario Argentino.
98 DESARROLLO SOSTENIBLE
Yerba mate/ 100 g de material Cebadura mg por porción Mate cocido mg por porción Extracto acuoso (g) 40,6 ± 0,82 14,5 ± 4,35 0,9 ± 0,02 Cenizas (g) 6,6 ± 0,12 1,6 ± 0,05 0,106 ±0,002 Cafeína (g) 1,1 ± 0,03 0,4 ± 0,01 0,031±0,001 Ácidos
14,7 ± 0,57 3,1 ± 0,11 0,29 ± 0,02
16,5
1,20 4,5 ± 0,33 0,45 ± 0,04 Sodio (mg) 6,7 ± 0,3 2,9 ± 0,12 0,29 ± 0,01 Potasio (mg) 1299 ± 32 760,7 ± 39,5 35,5 ± 1,0 Calcio (mg) 836 ± 18 7,6± 0,12 1,2 ± 0,01 Magnesio (mg) 716 ± 8 131,3 ± 2,7 8,3 ± 0,3
clorogénicos (g)
±
Tabla 3. Aportes nutricionales de las porciones de cebadura y mate cocido.
(B12) µg 2,5 0,454±0,187 11-26 0,025±0,008 0,7-1,6 Ác. L-ascórbico (C) mg 80
Ref.: (1) Según DRIs (Dietary Reference Intakes), Nielsen 2003, COT 2003, y otras estimaciones basadas en los requerimientos de hombres y mujeres entre 19 y 50 años de edad.- (2) Tamaño de la porción 50 g/500 mL.- (3) % del valor dietario (VD) sobre la base de una dieta diaria de 2000 kcal u 8400 kJ de acuerdo al Reglamento Técnico Mercosur.- (4) Tamaño de la porción: 3 g/200 mL.- Indet.: indeterminado
Se ha establecido como consumo diario promedio 400 mL/persona/ día (Maiocchi et al. 2011). Los resultados se presentan en la Tabla 4.
El MC+LE+Az debe ser considerado una fuente de nutrientes (carbohidratos, lípidos, proteínas, vitaminas, minerales) particularmente para escolares de 3-13 años de escuelas públicas, donde se ofrece en desayuno y/o merienda. Una doble porción diaria aporta entre 15 y 100% de la ingesta diaria recomendada de esos nutrientes. Destaca el aporte vitamínico (A, B1, B2, B5, B6, B7, B12 y K) y mineral (Mn, P, Cu, Zn, Fe, Ca, Mg, Na, Cl, K), libre de metales pesados y bajo colesterol. El efecto estimulante de la cafeína contribuye al mejor rendimiento escolar.
99 PRODUCTOS DEL NORDESTE ARGENTINO
Parámetros nutricionales unidades Ingesta diaria (1) Cebadura Mate cocido (2) % VD (3) (4) % VD (3) Valor energético kcal 2000 46,12±5,72 2,0-2,5 2,76±0,36 0,12-0,16 kJ 8400 194,2±24,1 11,62±1,52 Proteínas
46-56 1,31±0,19 2,0-3,2 0,08±0,01 0,1-0,2
0 0 0
g
Grasas totales g Indet. 0
- 0 0 0 0 Carbohidratos
130 10,22±1,24 6,8-7 0,61±0,08 0,4-0,5 Fibra dietaria total g 25-38 0 0 0 0 Vitamina A µg 800 84,1±20,05 8-13 5,21±1,6 0,5-1 Tiamina
mg 1,1 0,668±0,159 48-77 0 2,7-4,4 Riboflavina (B2) mg 1,4 0,386±0,137 18-37 0,0039±0,009 2-2,3 Niacina (B3) mg 16 1,22±0,35 5,5-10 0,019±0,007 0,3-0,6 Ác.
mg 6 2,03±0,77 21-47 0,069±0,013 1,2-3 Piridoxina
mg 1,3 0,447±0,189 20-49 0,129±0,084 1,2-3 Ác.
µg
3,07±0,73 3-4,7 0,179±0,036 0,2-0,3
Colesterol g
g
(B1)
pantonénico (B5)
(B6)
fólico (B9)
200-400 40,43±8,49 8-24,5 2,39±0,84 0,5-1,4 Cianocobalamina
Tabla 4. Valor Nutricional de Mate cocido (MC), Leche entera (LE) y Mate cocido+Leche entera+Azúcar (MC+Le+Az) por porción (200 mL).
Ref.: MC: mate cocido; LE: leche entera; Az: azúcar refinada; nd: no detectado; Indet.: indeterminado; porción: una taza mediana (100ml MC+100ml LE+10g Az = 200ml); (1) IDR: ingesta diaria recomendada, cubre necesidades de casi toda la población entre 3 y 13 años, basada en las DRIs (Dietary Reference Intakes, www. nap.edu) y otros (Nielsen 2003, COT 2003); (2) VD%: valor dietario, % de una dieta diaria de 1050-2550 kcal (4390-10660 kJ, FAO 2001).
El mate cocido (MC) por sí mismo no representa un alimento relevante, pero combinado 50:50 v/v con leche entera de vaca y adicionado de 10 g de azúcar refinado constituye un factor importante en la dieta. En efecto, considerando que los escolares deberían ingerir 2 porciones diarias de 200 mL cada una de MC+LE+Az, se duplican los valores diarios ingeridos con lo cual éste se convierte en un alimento de real importancia. Tomando en cuenta que las necesidades energéticas adecuadas para el intervalo etario entre 3 y 13 años
100
SOSTENIBLE
DESARROLLO
Parámetros Nutricionales unidad IDr (1) MC (100 mL) LE (100 mL) Az (10g) MC+LE+Az (200 mL) Σ en 200 mL %VD (2) Valor energético kcal 1050-2550 1,38 62,8 40,0 104,2±8,8 4,1-9,9 kJ 4390-10660 5,81 263,9 167,2 436,9±61,7 Proteínas g 15,5-44 0,04 3,24 0 3,3±0,1 7,4-21,2 Grasas totales g Indet. 0 3,37 0 3,4±1,2Colesterol mg lo < posible 0 10,3 0 10,3±0,6Carbohidratos g 130 0,30 5,20 9,95 15,4±0,9 11,8 Fibra dietaria total g 19-26 0 0 0 0 0 Vitamina A µg 400-600 0 47,42 0 47,4±5,6 7,9-11,8 Tiamina (B1) mg 0,6-0,9 0,01 0,05 0 0,06±0,01 6,6-10 Riboflavina (B2) mg 0,6-0,9 0,01 0,17 0 0,18±0,03 20-30 Niacina (B3) mg 8-12 0,02 0,09 0 0,11±0,02 0,9-1,4 Ác. pantoténico (B5) µg 3-4 0,03 0,38 0 0,41±0,02 10,2-13,6 Piridoxina (B6) mg 0,6-1 0,01 0,04 0 0,05±0,01 5-8,3 Ác. Fólico (B9) µg 200-300 0,61 5,15 0 5,8±0,9 1,9-2,8 Cianocobalamina (B12) µg 1,2-1,8 0,09 0,46 0 0,55±0,06 30,5-45,8 Vitamina C mg 25-45 0,61 0,99 0 1,6±0,1 3,5-6,4 α-tocoferol (E) mg 7-11 Nd 0,07 0 0,07±0,01 0,6-1 Vitamina K µg 55-60 Nd 0,31 0 0,31±0,02 0,5-0,6 Vitamina D µg 15 Nd 0,03 0 0,03±0,01 0,2 Biotina (B7) µg 12-20 Nd 20 0 20,0±3,2 100-166
(edad escolar) han sido establecidas entre 1.050 y 2.550 kcal (FAO/WHO 2001) es destacable que la ingesta indicada proporciona entre el 8-20% de esos valores, en tanto que también proporciona hasta el 42% de las proteínas requeridas, hasta el 23% de los carbohidratos, del 16 a 22% de la vitamina A, 20% de tiamina, 40 a 60% de riboflavina, 20 a 26% de ácido pantoténico, hasta 16% de piridoxina, 60 a 90% de cianocobalamina y duplica o triplica los requerimientos diarios de biotina.
7. P RODUCCIÓN y CONSUMO DE TÉ
El té [Camellia sinensis (L.) Kuntze] se cultiva en Argentina desde 1923, y ha convertido al país en el mayor productor de América, con cerca del 4% de la producción mundial. En 2017, se cultivaron 40.500 ha, de las que 2.500 correspondieron a Corrientes y 38.000 a Misiones, según datos de la Estación
Experimental Agropecuaria del INTA de Cerro Azul.
Se trata de un alimento consumido en general como infusión, que tiene una fuerte acción antioxidante, y por ello muestra propiedades anticancerígenas, inmunoestimulantes, y contra el envejecimiento celular. Presenta alta proporción de taninos, que le confieren su carácter astringente y amargo, y es estimulante del sistema nervioso central por la concentración de xantinas. También interesa por el contenido vitamínico, particularmente en vitaminas A, B2, B3, B6 y C, y el tenor de minerales, de los que sobresalen potasio, calcio, magnesio y manganeso.
En el comercio mundial se presentan numerosos tipos de té y fórmulas comerciales. Las que predominan son dos, el té negro, que ha sufrido un proceso de fermentación y desecación, y el té verde, que ha sido desecado a poco de cosechado, preservando el color de las hebras y con un sabor característico.
A menudo se encuentra al té asociado a otras hierbas, frutos, etc. y a veces se elabora con él bebidas de gran difusión en ciertos mercados. También la industria cosmética lo emplea en la formulación de cremas y lociones, particularmente por sus propiedades antioxidantes.
Las características distintivas de unos y otros tés dependen mayormente a las condiciones ambientales del lugar, tanto como a las prácticas agrícolas y a las de manufactura. En Argentina se busca elevar los estándares de calidad y el rendimiento agrícola, a través de la sustitución de plantaciones por híbridos mejorados y la aplicación de mayor tecnificación en los procesos. Un indicio de la mejora operada son los niveles de rendimiento, que casi duplican la media mundial, y la exportación, que han alcanzado al 1,3% del monto mundial.
La producción argentina se limita a 4 zonas, a saber: Centro-sur (que concentra el 42% de la superficie), Centro-norte (30%), Alto Paraná (16%), todas en Misiones, y la Zona de campos, distribuida en los departamentos limítrofes de Corrientes y Misiones, con el 12% de la superficie total.
101 PRODUCTOS DEL NORDESTE ARGENTINO
El té argentino se emplea mayormente como base o como adición para las mezclas (“blends”) que caracterizan a cada marca comercial. Precisamente las propiedades sensoriales y la homogeneidad de cada partida son muy relevantes tanto en la determinación de la calidad como de la valoración monetaria. La evolución de las condiciones locales y sobre todo internacionales para este producto lo convierten en una alternativa favorable en términos económicos y sociales, ya que su incremento traería aparejado un mayor índice de empleo y ayudaría a consolidar la población rural, evitando el éxodo que ha caracterizado las variaciones poblacionales de la región.
8. P RODUCCIÓN y CONSUMO DE PLANTAS MEDICINALES y AROMÁTICAS
A nivel global, las plantas aromáticas y medicinales (PAM) y derivados representan un rubro de importancia entre los cultivos con mayor tecnificación, alcanzando altos valores de mercado. Tienen aplicación en fresco o como droga cruda, y mediante transformaciones industriales intervienen en la manufactura de medicamentos, nutracéuticos, cosméticos, bebidas y extracto. Las modalidades de consumo más tradicionales de estas plantas son formas farmacéuticas simples como infusiones, decocciones y extractos alcohólicos o hidroalcohólicos, que por otra parte requieren al menos los procesos de estabilización y estandarización para una dosificación adecuada, y para satisfacer las condiciones ineludibles de todo medicamento: calidad, seguridad y eficacia.
El uso y comercio de PAM en todo el mundo tiene gran importancia, ya que cerca del 80% de la población cuenta con la medicina natural (mayormente PAM) para satisfacer sus necesidades primarias de salud, por un lado por razones culturales y por otro porque en amplias zonas no existen farmacias para proveer medicamentos industriales (Akerele 1993, Alonso 2003, Zhang 1998). Además, al menos el 25% de las drogas de uso clínico son metabolitos obtenidos de plantas superiores (Kinghorn y Balandrin 1993). Ello ha incrementado el esfuerzo científico para conocer la identidad de las plantas salutíferas, su composición química y la validación farmacológica de acciones y propiedades terapéuticas del uso popular. La OMS apoya el empleo de las medicinas tradicionales en la atención primaria de salud (APS), en tanto hayan sido utilizadas durante décadas por etnias determinadas sin mostrar efectos colaterales o toxicidad aguda (WHO 2002).
Estas plantas constituyen un segmento de importancia creciente en la cadena productiva y la comercialización de productos de base agraria, en nuestro país y en el mundo. Sin embargo, frente a los grandes volúmenes de los cultivos tradicionales y las commodities, en Argentina las PAM representan un grupo menor en cuanto a superficie implantada y valor económico.
Las condiciones favorables de suelo y clima del Nordeste, además de una flora medicinal y aromática muy variada y un gran acervo popular en el uso
102 DESARROLLO SOSTENIBLE
y aplicación de las mismas (Litovsky 2005), que resulta de la síntesis de saberes indígenas y europeos (Jofré Gutiérrez et al. 2017), representan una gran oportunidad para explotar las PAM. El cultivo se adapta al sistema de minifundios, y agrega valor social cuando es realizado por pequeños productores y núcleos comunitarios indígenas. Estas ventajas comparativas pueden ser usadas para aumentar la colocación en mercados externos. Una posibilidad cierta es la producción en condiciones de cultivo orgánico, y la potencial transformación de esa materia prima de excelencia abre caminos a la exportación. En efecto, para la producción de metabolitos secundarios de interés farmacéutico, los cultivos orgánicos, los realizados bajo cubierta, los cultivos in vitro en sus diversas modalidades, y otras formas muy tecnificadas, aparecen como alternativas ventajosas ante los cultivos tradicionales intensivos, con protocolos homologados a nivel internacional para las plantas medicinales más conocidas. En cuanto a los aceites esenciales, Argentina ocupa el 6º lugar en exportación, y el 1º en aceite esencial de limón. Los aceites esenciales no cítricos también tienen grandes perspectivas de producción y exportación. En 2012, las exportaciones argentinas alcanzaron unas 3.200 t/año, con un valor superior a los 10 millones de dólares, e involucran mayormente a 4 especies: manzanilla, coriandro, orégano y albahaca (Argentina 2012). Por su parte, no hay datos fidedignos del comercio local, pero se presume de importancia por la cantidad de productos y rubros que abarca. Se estima que hasta el 60% de la producción de PAM procede de poblaciones silvestres, y por ello están expuestas a sustituciones y/o adulteraciones, que afectan severamente su calidad. La incorporación al cultivo de la mayoría de las PAM autóctonas generalmente requiere de sucesivos procesos de domesticación y selección, multiplicación a escala de cultivo, establecimiento de las buenas prácticas agrícolas y de recolección (BPAR) de la Organización Mundial de la Salud (OMS) para plantas aromáticas y medicinales. Además, se requiere buenas prácticas de manufactura (BPM) para su industrialización, así como la determinación de los parámetros para la conservación del producto terminado. Paralelamente deberá desarrollarse un adecuado esquema de comercialización, con un control continuo sobre todos los procesos, que conduzcan a la obtención de un producto de óptima calidad, seguro y eficaz. Todavia, el extractivismo seguirá siendo alto, obligando a establecer pautas de manejo para alcanzar una explotación racional y sostenible de las PAM de la región. Otros factores a tener en cuenta son la existencia de variedades botánicas y fitoquímicas, los factores ecológicos, el origen geográfico, los estadíos fenológicos de la planta, la estandarización y normalización del producto, determinantes de su calidad final Las PAM nativas más frecuentemente empleadas en el NEA son mencionadas en la Tabla 5. Numerosos autores se han ocupado de las PAM del Nordeste del país y de sus usos etnobotánicos, desde las antiguas obras prelinneanas de los jesuítas Montenegro, Sánchez Labrador, Paucke, etc. hasta las más modernas de etnobotánica cuantitativa.
103 PRODUCTOS DEL NORDESTE ARGENTINO
Tabla 5. Principales plantas medicinales y aromáticas del Nordeste Argentino.
Nombre comun
Nombre científico
Abrojos Xanthium spp
Agrial Begonia cucullata
Aguapés, Camalotes Pontederia azurea, P. crassipes
Aguaribay Schinus areira
Algarrobos Prosopis spp
Ambay Cecropia pachystachya
Ambay guasú Schefflera morototoni
Anchico colorado Parapiptadenia rigida
Aratikú Annona emarginata
Barba de choclo, Maíz Zea mays
Barbasco Buddleja brasiliensis
Burrito Aloysia polystachya
Caá-berá Croton urucurana
Cabotorí Hypericum connatum
Café de Bonpland Senna occidentalis
Nombre comun
Mata hura
Mboi poä
Mil hombres
Molles
Ñangapirí
Ñaurandís
Ombú
Ortiga
Ortiga brava
Paicos
Palán-palán
Paletaria
Nombre científico
Sebastiania brasiliensis
Ibicella lutea
Aristolochia triangularis
Lithraea molleoides, Schinus fasciculatus
Eugenia uniflora
Piper spp.
Phytolacca dioica
Urtica spp
Urera spp
Dysphania spp.
Nicotiana glauca
Parietaria debilis
Palo amargo Picrasmia crenata
Palo santo Bulnesia sarmientoi
Parí paroba
Piper dilatatum
Calagualas Campyloneuron major, Phyllitis brasiliensis Pasionarias Passiflora spp
Cambará Lantana camara
Congorosa Maytenus ilicifolia
Caraguatás Bromelia spp
Caranday Copernicia alba
Cardo santo Argemone subfusiformis
Carne de vaca Styrax leprosus
Carne gorda Talinum fruticosum
Carobas Jacaranda spp
Carquejas Baccharis spp
Peludilla Gomphrena celosioides
Penicilina
Alternanthera philoxeroides
Peteribí Cordia trichotoma
Pezuña de vaca
Bauhinia forficata pruinosa
Pindó Syagrus romanzoffiana
Pipí Petiveria alliacea
Quebracho blanco
Aspidosperma quebracho-blanco
Quebrachos colorados Schinopsis spp
Quiebrarado Heimia salicifolia
Cedros Cedrela spp. Rompepiedras Phyllanthus spp.
Ceibo Erythrina crista-galli
Chañar Geoffroea decorticans
Chinchilla Tagetes minuta
Cocú Allophyllus edulis
Cola de caballo Equisetum giganteum
Coquito Acrocomia totai
Culantrillo Adiantum spp
Cupay Copaifera langsdorfii
Curupí Sapium haematospermum
Doradilla Hemionitis tomentosa
Doradillas Anemia spp
Espina de corona Gleditsia amorphoides
Espinillos Mimosa spp
Flor de patito Aristolochia spp
Flor de piedra Lophophytum leandri
Fumo bravo Solanum granuloso-leprosum
Grapia Apuleia leiocarpa
Guabiyú Myrcianthes pungens
Guavirá Campomanesia xanthocarpa
Guayabo Psidium guajava
Guayaibí Patagonula americana
Horquetero Tabernaemontana catharinensis
Incienso Myrocarpus frondosus
Ingás Inga spp
Jaborandí Pilocarpus pennatifolius
Kaá ehe’e Stevia rebaudiana
Kaá taís Polygonum spp
Lapachos Tabebuia spp
Laureles Nectandra spp
Laureles Ocotea spp
Llantenes Plantago spp
Malvas Malva spp, Sphaeralcea spp
Mamón Carica papaya
Marcelas, Marcelitas Achyrocline spp
Salvia morada Lippia alba
Samohú Ceiba insignis
Sarandí blanco Phyllanthus sellowianus
Sauce criollo Salix humboldtiana
Sauco Sambucus australis
Siete sangrías Cuphea spp
Sota caballo Luehea divaricata
Suelda con suelda Microgramma vacciniifolia
Tacuarembó Chusquea ramosissima
Tacuaruzú Guadua trinii
Talas Celtis spp
Tapecués Acanthospermum spp
Taropé Dorstenia brasiliensis
Tarumá Citharexylum montevidense
Tayuyás Cayaponia spp
Timbó, Pacará Enterolobium contortisiliquum
Toro kaá
Pterocaulon balansae
Tutiá Solanum sisymbriifolium
Uñas de gato
Macfadyena spp
Urunday Astronium balansae
Urunguay Dioclea violacea
Viraró Pterogyne nitens
Vira-viras Pseudognaphalium spp
Yatay
Butia yatay
Ybirá pytá, cañafístola Peltophorum dubium
Yerba carnicera Conyza bonariensis
Yerba del pollo Alternanthera pungens
Yerba lucera
Pluchea sagittalis
Yerba mate Ilex paraguariensis
Yerba pajarito
Phoradendron piperoides
Yerbas de la golondrina Euphorbia spp
Yvapurú, Jaboticaba Myrciaria truncifolia
Yvirá pajú
Zarzaparrillas
Aspidosperma australe
Herreria montevidensis, Smilax campestris
104
DESARROLLO SOSTENIBLE
La rica flora de la región fue empleada diversamente por los indígenas, y cada etnia considera medicinales cierto número de plantas. A modo de ejemplo, se ha citado 119 especies en la farmacopea de los tobas del Este del Chaco (Martínez-Crovetto 1964), y unas 125 para los mocovíes (Martínez-Crovetto 1968); los Lengua emplean 41 especies (Arenas 1981), y 37 especies los Maká (Arenas 1987). Amat & Yajía (1998) han relevado 282 especies medicinales nativas y exóticas para la Provincia de Misiones, y Scarpa & Rosso (2014) han elevado a 221 las especies, mayormente nativas, que utilizan como medicinales los Mocovíes. Recientemente, Kujawska et al. (2017) han relevado casi 400 especies nativas utilizadas actualmente por los Guaraníes.
CONSIDErACIONES FINALES
Se consideran las condiciones y perspectivas de la producción y consumo de hierbas para infusiones en el Nordeste argentino. La región presenta ambientes inmejorables para la producción agrícola de yerba mate y té, que actualmente tiene un gran impacto socioeconómico regional y una importante participación en el mercado nacional y mundial. Asimismo, más de un centenar de especies medicinales, aromáticas y condimenticias (PAM), tanto nativas como exóticas, forman parte del comercio y del acervo popular de la región.
Las etnias originarias han marcado el camino en el descubrimiento de sus propiedades medicinales, alimenticias, etc., las que siguen siendo empleadas en nuestros días y representan una materia prima de excelencia en las diversas industrias relacionadas. Las condiciones de suelo y clima favorecen su explotación racional y sustentable, con potencial impacto en las condiciones socioeconómicas y las cadenas de producción y comercialización de base agraria, en la región y el país.
R EFERENCIAS BIBLIOGRÁFICAS
Akerele O (1993) Las plantas medicinales: un tesoro que no debemos desperdiciar, Foro Mundial de la Salud, 14:390-395. Alonso JR (2003) Bosques y selvas tropicales como fuentes de medicamentos. Boletin Latinoamericano y del Caribe de Plantas Medicinales y Aromaticas, 2(2):16-21.
Alzate C, Mertens F, Fillion M, Rozin A (2019). The study and use of traditional knowledge in agroecological contexts, Revista de la Facultad de Ciencias Agrarias de la Universidad Nacional de Cuyo, 51:(1):337-350.
Amat AG, Yajía M (1998) Plantas vasculares utilizadas en la fitoterapia popular de la Provincia de Misiones, Argentina, En: Farmacobotánica y farmacognosia en Argentina (1980-1998). Ediciones Científicas Americanas, La Plata, pp.119–152.
105 PRODUCTOS DEL NORDESTE ARGENTINO
Anesini C, Ferraro G, Filip R (2005). Peroxidase-like activity of Ilex paraguariensis. Food Chemistry, 97 (3): 459-64.
Arenas P (1981) Etnobotánica Lengua-Maskoy. FECIC, Buenos Aires, 348p.
Arenas P (1987) Medicine and magic among the Maká indians of the Paraguayan Chaco. Journal of Ethnopharmacology, 21:279-295.
Arenas P (1992) El Chaco, su gente y las plantas. Universidad de Córdoba, España, 50p.
Arenas P (2009) Los estudios sobre medicina y farmacopea vernácula en el Gran Chaco. Rojasiana, 8(2):81-100.
Arenas P (2012) Etnobotánica en zonas áridas y semiáridas del Cono Sur de América. CEFYBO/CONICET/UBA, Buenos Aires, 272p.
Argentina (2012) Anuario Alimentos Argentinos 2012. http://www.alimentosargentinos.gob.ar/contenido/sectores/aromaticas/informes/Info_Aromaticas_08_2012_08Ago.pdf Acceso Marzo 2019.
Argentina (2017) Estrategia Nacional sobre la Biodiversidad-Plan de Acción 2016-2020. http://servicios.infoleg.gob.ar/infolegInternet/anexos/270000-274999/273039/res151.pdf. Acceso Marzo 2019.
Argentina (2019) Región del Noreste. http://www.mininterior.gov.ar/municipios/gestion/regiones_archivos/NEA.pdf. Accesso Mayo 2019.
Bastos D, Fornari A, de Queiroz Y, Torres E (2006) Bioactive compounds content of chimarrão infusions related to the moisture of yerba mate (Ilex paraguariensis) leaves. Brazilian Archives of Biology and Technology, 49:399-404.
Bixby M et al. (2005) Ilex paraguariensis extracts are potent inhibitors of nitrosative stress: A comparative study with green tea and wines using a protein nitration model and mammalian cell cytotoxicity. Life Sciences, 77:345-58.
Bonfils CG (1970) Los recursos edáficos del Nordeste argentino y el Este del Paraguay. Boletin de la Sociedad Argentina de Botanica, 11:103-110.
Bracesco N et al. (2011). Recent advances on Ilex paraguariensis research: Minireview. Journal of Ethnopharmacology, 136: 378-384.
Burgos JJ (1970) El clima de la región noreste de la República Argentina en relación con la vegetación natural y el suelo. Boletín de la Sociedad Argentina de Botánica, 11:37-101.
Burkart R, Bárbaro NO, Sánchez RO, Gómez DA (1999) Eco-regiones de la Argentina. Administración de Parques Nacionales/Programa Desarrollo Institucional Ambiental, Buenos Aires, 20p.
CAA (2019) Código Alimentario Argentino. http://www.anmat.gov.ar/alimentos/codigoa/CAPITULO_XV.pdf. Obtenido de http://www.anmat.gov.ar/alimentos/codigoa/CAPITULO_XV.pdf. Acceso Junio 2019.
Cabrera AL (1976) Regiones fitogeográficas argentinas. En: Enciclopedia Argentina de Agricultura y Jardinería II, fasc. 1. ACME, Buenos Aires, pp.1-85.
Cadenas de valor yerba mate (2019) https://www.economia.gob.ar/peconomica/docs/2018/SSPMicro_Cadenas_de_valor_Yerba_Mate.pdf. Acceso Junio 2019.
106 DESARROLLO SOSTENIBLE
Cappelari P et al. (2017) Yerba mate. Reseña histórica y Estadística. Producción e Industrialización en el siglo XXI. Consejo Federal de Inversiones, Buenos Aires, 300p.
Carlino A (2009) Los orígenes de la industria algodonera en el Territorio Nacional del Chaco. Instalación del desmotado y las aceiterías. H-industri@, 3(5):1-22.
Catterberg G, Mercado R (2017) Informe Nacional sobre Desarrollo Humano 2017. En: Información para el desarrollo sostenible: Argentina y la Agenda 2030. PNUD, Buenos Aires, pp.1-184.
Chaves M, Maiocchi M, Sgroppo S, Avanza JP (2002). Poder antioxidante de infusiones de Ilex paraguariensis (St. Hil.). Revista de Información Técnica 3:1-8.
COT CO (2016) Committee on Toxicity of Chemicals in Food, Consumer Products and the Environment. http://www.food.gov.uk/multimedia/pdfs/ TOX. http://www.food.gov.uk/multimedia/pdfs/TOX: http://www.food.gov. uk/multimedia/pdfs/TOX. Acceso Marzo 2016.
CRYM (1971) Comisión Reguladora de la Producción de la Yerba Mate. Buenos Aires: Ministerio de Agricultura y Ganadería, 20p.
Del Valle Argüello B, Scipioni G (2015) La yerba mate, Tecnología de la Producción y Propiedades. En: Schmalko M, Krikun S, Känzig R. Editorial Universitaria. Posadas, Misiones, 436p.
Delfino M (1990) Extractabilidad de Hierro y Manganeso en Yerba Mate en condiciones de consumo. Revista Facena, 8:122-130.
Dellacassa E et al. (2007) Yerba mate. Historia, uso y propiedades. Revista de la Asociación de Quimica y Farmacia del Uruguay, 51:16-20.
FAO/WHO (2001) Human Energy Requirements. Roma: FAO/WHO, 96p.
Filip R, López P, Giberti G, Coussio J, Ferraro G (2001) Phenolic compounds in seven South American Ilex species. Fitoterapia, 72(7):774-778.
Grondona EM (1953) Historia de la yerba mate. Revista Argentina de Agronomía, 20(2):68-95.
Hart F, Fischer H (1984) Análisis Moderno de Alimentos. Zaragoza, España, 619p.
Heck C, Mejía E (2007) Yerba Mate Tea (Ilex paraguariensis): A comprehensive review on chemistry, health implications, and technological considerations. Journal of Food Science, 72:138-51.
INDEC (2012) Censo nacional de población, hogares y viviendas 2010: resultados definitivos, Serie B-2, 1ed. Instituto Nacional de Estadística y Censos, Buenos Aires, 378p.
INDEC (2015) Censo Nacional de Población, Hogares y Viviendas 2010. Pueblos originarios: región Nordeste Argentino. Instituto Nacional de Estadística y Censos, Buenos Aires. https://www.indec.gov.ar/ftp/cuadros/poblacion/ pueblos_originarios_NEA.pdf. Acceso Junio 2019.
107 PRODUCTOS DEL NORDESTE ARGENTINO
INDEC (2019) Intercambio comercial argentino Cifras estimadas de mayo de 2019 ISSN 2545-6636. www.indec.gob.ar/uploads/informesdeprensa/ ica_06_198F36433106.pdf. Acceso Junio 2019.
INYM (2019) https://www.inym.org.ar/wp-content/uploads/2019/05/estadisticas-yerba-mate-inym-abril-2019. Acceso Mayo 2019.
Jofré GME, Cardoso SP, Petenatti EM, Del Vitto LA (2017) La Materia Médica Misionera (ca. 1711) y las plantas de uso ginecológico: una relación intercultural. Dominguezia, 33(1):38-38.
Kinghorn AD, Balandrin MF (1993) Human medicinal agents from plants. ACS Symposium Series, 534:1-356.
Krapovickas A (1970) Historia de la Botánica en Corrientes. Boletín de la Sociedad Argentina de Botánica,11:229-276.
Kujawska M, Hilgert NI, Keller HA, Gil G (2017) Medicinal plant diversity and inter-cultural interactions between indigenous Guarani, Criollos and Polish migrants in the subtropics of Argentina. PLoS One, 12(1):e0169373.
Litovsky M (2005) Plantas medicinales de América del Sur. Diálogo de saberes para la sustentabilidad. http://cetsur.org/wp-content/uploads/2016/09/ Plantas-medicinales-de-America-del-Sur.pdf. Acceso Febrero 2018.
Lunceford N, Gugliucci A (2005) Ilex paraguariensis extracts inhibit AGE formation more efficiently than green tea. Fitoterapia, 76:419-427.
Maiocchi M (2017) Composición Química. En C. y. otros, Yerba Mate. Reseña história y Estadística. Producción e Industrialización en el S XXI. Buenos Aires: Consejo Federal de Inversiones, pp.77-92.
Maiocchi M et al. (2018) Nutritional parameters of «mate cocido» with milk prepared from two species of Ilex and their commercial mix. Revista de la Facultad de Ciencias Agrarias - UNCuyo, 50(2):203-216.
Maiocchi M et al. (2016) Multielemental composition and nutritional value of «dumosa» (Ilex dumosa), «yerba mate» (I. paraguariensis). evista de la Facultad de Ciencias Agrarias - UNCuyo, 48(1):145-159.
Maiocchi M, Téves M, Del Vitto LA, Avanza M, Petenatti EM (2011) Comparative physicochemical parameters of infusion of two species of Ilex. Biocell, 35, pp.54.
Maiocchi M, Avanza J, Moyano S, Martínez L (2002) Estudio comparativo del contenido de minerales en Ilex paraguariensis e Ilex dumosa. Actas IX Congreso Argentino de Ciencia y Tecnología de Alimentos, Buenos Aires. 468 p. Manzoni C (2019) https://www.lanacion.com.ar/economia/el-argentino-sigue-fiel-a-las-infusiones-nid2235708. Acesso Junio 2019.
Martínez GJ (2012) Recolección, disponibilidad y uso de plantas en la actividad artesanal de comunidades Tobas (Qom) del Chaco Central (Argentina). En: Etnobotánica en zonas áridas y semiáridas del Cono Sur de Sudamérica. CEFYBO/Conicet, Buenos Aires, pp.195-224.
Martínez-Crovetto R (1964) Estudios etnobotánicos 1. Nombres de plantas y su utilidad, según los indios Tobas del este del Cahaco. Bonplandia, 1(4):279333.
108 DESARROLLO SOSTENIBLE
Martínez-Crovetto R (1968) Introducción a la etnobotánica del Nordeste Argentino, Etnobiológica, 11:1-10.
Martínez-Crovetto R (1970a) La etnobotánica de los grupos aborígenes del Nordeste argentino. Boletín de la Sociedad Argentina de Botánica, 11:211-215.
Martínez-Crovetto R (1970.b). Etnografía del Nordeste argentino. Boletín de la Sociedad Argentina de Botánica, 11:217-222.
Martinez-Crovetto R (1981) Las plantas utilizadas en medicina popular en el noroeste de Corrientes (República Argentina). Miscelánea Inst. M. Lillo, 69:1-139.
Morello JH (1970) Ecología del Chaco. Boletín de la Sociedad Argentina de Botánica, 11:161-174.
Nielsen F (2003) Boro, manganeso, molibdeno y otros oligoelementos. En: Conocimientos actuales sobre nutrición, 8ed, Bowman & Russell. 592p.
Nodal (2019) Yerba mate, una producción autóctona. https://www.nodal. am/2018/07/yerba-mate-una-produccion-autoctona.Acceso Junio 2019.
Ovando A (2019) www.cronista.com/apertura-negocio/empresas/Por-mayor-demanda-externa-preven-repunte-para-el-mercado-de-infusiones-20190326-0008.html. Acceso Junio 2019.
Panigatti JL (2010) Argentina 200 años, 200 suelos. Instituto Nacional de Tecnología Agropecuaria, Buenos Aires. https://inta.gob.ar/sites/default/files/ script-tmp-inta-200-suelos.pdf. Acceso Junio 2019.
Popolizio E (1970) Algunos rasgos de la geomorfología del Nordeste argentino. Boletín de la Sociedad Argentina de Botánica, 11:17-34.
Ragonese AE, Castiglioni JC (1970) La vegetación del Parque Chaqueño. Boletín de la Sociedad Argentina de Botánica, 11:133-160.
Ramallo L, Smorczewski M, Valdez E, Paredes A, Schmalko M (1997). Composición química del extracto acuoso de yerba mate. Congresso Sul-Americano da Erva-Mate. Anais da EMBRAPA, Curitiba: 411-12.
Ramilo D (2011) Agricultura familiar: Atlas. En: Población y agricultura familiar en la región NEA, v. 6. INTA, Buenos Aires, 48.pp.
Ramírez-Mares M, Chandra S, Mejía G (2004) In vitro chemopreventive activity of Camellia sinensis, Ilex paraguariensis and Ardisia compressa tea extracts and selected polyphenols. Mutation Research, 554(1-2):53-65.
Ringuelet RA (1970) Panorama general de la fauna y de sus relaciones del NE. Argentino y del Dominio Subtropical. Boletín de la Sociedad Argentina de Botánica, 11:175-183.
Robards K, Prenzler P, Tucker G, Swatsitang P, Glover W (1999). Phenolic compounds and their role in oxidative processes in fruits. Food Chemistry, 66:401-436.
Scarpa GF, Rosso CN (2014) La etnobotánica Moqoit inédita de Raúl Martínez Crovetto II: Descripción, actualización y análisis de los usos de las plantas. Bonplandia, 23(2):133-141.
109 PRODUCTOS DEL NORDESTE ARGENTINO
Schinella G, Fantinelli J, Mosca S (2005) Cardioprotective effects of Ilex paraguariensis extract: evidence for a nitric oxide-dependent mechanism. Clinical Nutrition, 24(3):360-6.
Schumacher EF (2010) Small Is Beautiful: Economics as if People Mattered. Harper Perennial, New York, 384p.
Tenorio Sanz M, Isasa MT (1991) Elementos minerales en la yerba mate (Ilex paraguariensis St. Hil.). ARCH Nutrition, 41:441-454.
Viera C, Sabbatella O (2011) Validación de métodos para medir sólidos solubles extraídos durante el consumo de yerba mate en forma de mateada. Actas 5°Congreso Sudamericano de la Yerba Mate. Posada. 394p.
WHO (2002) World Health Organization, General guidelines for methodologies on research and evaluation of traditional medicine. WHO, Geneva, 71p. World Wildlife Fundation (2019) Ecoregions. https://www.worldwildlife.org/ biomes. Acceso Marzo 2019.
Zarrilli AG (2004) Historia y economía del bosque chaqueño: la mercantilización de los recursos forestales (1890-1950). Anuario IEHS, 19:255-283.
Zhang X (1998) Investigación y regulación de las plantas medicinales. Natura medicatrix 49:7-12.
110 DESARROLLO SOSTENIBLE
7
METODOLOGÍAS PARA EL DESARROLLO DE ECOFUNGICIDAS BASADOS EN ACEITES ESENCIALES
Elena Pérez Faggiani¹ & Eduardo Dellacassa Beltrame²
1 Instituto Nacional de Investigación Agropecuaria (INIA), Programa Nacional de Investigación en Producción Citrícola, Camino al Terrible s/n, Salto, Uruguay. E-mail: elenaperez@inia.org.uy
2 Universidad de la República (UdelaR), Laboratorio de Biotecnología de Aromas, Facultad de Química, Departamento de Química Orgánica, General Flores 2124, 11800 Montevideo, Uruguay. E-mail: edellac@fq.edu.uy
INTRODUCCIÓN
Desde los comienzos de la agricultura, los cultivos han sido afectados por enfermedades que provocan severas pérdidas en la producción y el acopio de alimentos. Sin embargo, no es hasta el siglo XIX, a partir fundamentalmente de los trabajos realizados por Issac Prévost (1807) y Antón De Bary (1861), que se descubre que los hongos eran agentes causales y no consecuencia de las enfermedades como se creía en el siglo XVIII (Gianessi y Reigner 2006). Por ello, determinar la historia de los fungicidas en la “era antigua” (desde los orígenes hasta el siglo XVIII) ha sido un tema complejo y sustentado en la interpretación de obras literarias entre otros materiales (Mc Callan 1967). El control de las enfermedades en la “era moderna” surge en la etapa conocida como Revolución Industrial, cuando en 1880 se descubre en Francia que una mezcla de sulfato de cobre con cal (conocido como caldo bordelés) reducía en vides las pérdidas provocadas por el hongo Plasmopara vitícola (mildiu de la vid) (Gianessi y Reigner 2006). Los primeros productos sintéticos fueron producidos a mediados del siglo XX (Bedmar 2011). Luego de la segunda guerra mundial por su bajo costo, eficiencia y practicidad de uso fueron muy fomentados, bien aceptados por los productores y son utilizados masivamente hasta nuestros días. Sin embargo, en la segunda mitad del siglo XX con el avance de la ciencia, se descubrieron los efectos negativos de las moléculas sintetizadas sobre los seres humanos y componentes del medio ambiente (Stenersen 2004, Rabbinge y van Oijen 1997) modificándose el enfoque en la protección de los cultivos. En la actualidad existe preocupación de los consumidores y de muchos investigadores por encontrar alternativas a los fungicidas de síntesis que sean efectivos y sin efectos negativos sobre los seres humanos y el medio ambiente en general (aguas, suelos, flora, fauna y microorganismos benéficos). Los ecofungicidas se pueden definir como “fungicidas ecológicos” porque en su desarrollo, se busca que el producto final sea amigable con el medio
111
Stadnik MJ, Velho AC, Zorrilla SE (eds.) Desarrollo Sostenible en la Producción Agroalimentaria
ambiente e inocuo para la salud humana (Zaker 2016). Cuando el principio activo es obtenido de las plantas, pueden ser llamados también “fungicidas botánicos” (Al-Samarrai et al. 2012).
Los aceites esenciales son productos del metabolismo secundario de las plantas formados por una mezcla de compuestos volátiles que pueden tener actividad biológica (Bakkali et al. 2008, Zygadlo 2011). Son muy conocidos por su uso en la aromaterapia (Bagetta et al. 2016), en la conservación de alimentos (Calo et al. 2015), por sus propiedades antioxidantes y cosméticas (Antignac et al. 2011), anticancerígenas (Burkey et al. 2000) y contra patógenos humanos (Chouhan et al. 2017). A su vez, se ha demostrado el efecto insecticida (Isman et al. 2011) y el potencial de uso veterinario para el control de parásitos (López et al. 2014; Araújo et al. 2010). En el caso del control de las enfermedades de las plantas, se conoce el efecto que tienen en la inhibición del crecimiento y/o la reproducción de hongos y bacterias (Abd-AllA et al. 2011, Al-Samarrai et al. 2012, Badawy et al. 2011, Khaledi et al. 2014). A pesar de ello, son pocos los productos desarrollados a nivel comercial (Borges et al. 2018). Uno de los mayores problemas en la adopción es que existen dudas sobre la efectividad en relación a los fungicidas de síntesis (Kouassi et al. 2012). En Uruguay, el Instituto Nacional de Investigación Agropecuaria (INIA) en conjunto con la Facultad de Química de la Universidad de la República (UdelaR) iniciaron en el año 2012 líneas de investigación con el propósito de conocer el potencial de las plantas nativas de Uruguay para el desarrollo de ecofungicidas. Los mayores avances se han obtenido a partir del estudio de los aceites esenciales. Se ha avanzado en: a) la caracterización química de los componentes principales y su variabilidad dentro de una misma especie considerando distintas poblaciones y localidades (Umpierrez 2016), b) el efecto in vitro de por lo menos 15 aceites esenciales sobre algunos hongos y bacterias fitopatógenos (Lombardo et al. 2016, García-Roche 2014), c) evaluaciones en vivo a escala de laboratorio (Umpierrez et al. 2014, Lombardo et al. 2016). A continuación, se presentarán metodologías que se aplican para evaluar in vitro el efecto fungicida de los aceites esenciales y los métodos que fueron implementados por nuestro laboratorio para estudios en vivo a pequeña escala.
1. ENSAYOS IN VITRO
Los procedimientos utilizados convencionalmente para evaluar el efecto biocida de los aceites esenciales sobre microorganismos se basan en técnicas microbiológicas clásicas (Fig. 1) (Alilou et al. 2008, Dixit et al. 1995, Helander et al. 1998, Klieber et al. 2002, Smith et al. 2013, Tullio et al. 2007). El hecho de que no se disponga de protocolos estandarizados, determina que se utilicen diferentes metodologías de acuerdo al objetivo específico de la investigación publicada, el tipo de hongo en estudio, la preferencia del investigador y
112 DESARROLLO SOSTENIBLE
las instalaciones disponibles (Engelmeier y Hadacek 2006). Por ello, se sugiere tener en cuentas las normas y pautas sugeridas para asistir a los laboratorios de microbiología clínica por el Laboratorio de Instituto de Normas Clínicas y de Laboratorio (Engelmeier y Hadacek 2006).
Disco
Métodos de difusión
Métodos microbiológicos para la deteccion de actividad biológica




Métodos de diluición


Bioautobiografia




Cilindro


Ensayo de plancha caliente

Dilución en agar


Ensayo en tubo


Contacto


Inmersión


Directo


Figura 1. Clasificación de los métodos microbiológicos para la detección de actividad biológica. Fuente: Choma y Grzelak (2011).
En el caso de los hongos y bacterias que afectan a las plantas, la selección de los métodos más adecuados puede estar condicionada por las características del patógeno (Kouassi et al. 2012), tales como, el hecho de ser un parásito obligado o facultativo, la velocidad de crecimiento in vitro, de esporulación, etc. Luego, entre aquellas técnicas que se adaptan a las condiciones del patógeno y que proporcionan la misma información, cada equipo de investigación debe resolver cuáles usar considerando las condiciones de su laboratorio (equipos, materiales, recursos humanos y infraestructura que posea).
En nuestra experiencia, cuando es necesario probar muchos compuestos a la vez, frente a un mismo fitopatógeno o viceversa, recomendamos empezar por ensayos cualitativos que permitan discriminar en forma rápida la bioactividad de los productos evaluados (primera etapa). Luego, aquellos promisorios, serán sometidos a pruebas cuantitativas para conocer las concentraciones mínimas inhibitorias (CMI), efecto biocida o bioestático (segunda etapa). Finalmente, se recomienda continuar con ensayos de control del patógeno sobre el hospedero (in vivo) en una escala pequeña generalmente definida como semi comercial (ensayos in vivo). Esta etapa es fundamental para conocer de una forma económica y efectiva el potencial de control en vivo de los productos seleccionados. Los experimentos pueden ser diseñados para
113 DESARROLLO DE ECOFUNGICIDAS
optimizar la forma de aplicación, evaluar si el efecto es curativo o preventivo sobre las enfermedades y contar con una mejor estimación de la cantidad de aceite esencial que deberá utilizarse a escala industrial para obtener un nivel de control comercialmente aceptable. Muchas veces, los resultados promisorios obtenidos en las pruebas in vitro no se reproducen en presencia del hospedero, o para que el control de la enfermedad sea aceptable, se necesitan aplicar concentraciones tan altas del aceite esencial que lo convierten en una alternativa no viable a nivel comercial.
Los resultados que se obtienen in vitro en las evaluaciones de los aceites esenciales independiente de la metodología utilizada suelen expresarse como μg/cm3 (Qayumi et al. 2007). No obstante, a nivel experimental puede resultar más conveniente medir el volumen en microlitros (mm3) y calcular el equivalente en microgramos considerando una densidad = 1 para todos los aceites esenciales (Pauli y Schilcher 2010).
1.1 Primera etapa
1.1.1 Métodos de difusión
Los métodos de difusión fueron desarrollados tempranamente para conocer el efecto de los antibióticos sobre bacterias (Wanger 2007). Consisten en colocar el agente antimicrobiano de interés en un soporte en el que tenga la capacidad de difundir. Cuando el medio es agar, el método es conocido como “Ensayo de difusión en Agar” (Vicente y Peláez 2007). Si bien existen muchas variantes de esta técnica, consiste fundamentalmente en colocar una suspensión conocida del microorganismo de interés (esporas de hongos o células bacterianas) en un medio de cultivo que es dispensado en placas de Petri.
Cuando se analizan aceites esenciales, el mismo es aplicado en un reservorio que permite su difusión a través del medio de cultivo disminuyendo su concentración a medida que se aleja del reservorio. El microorganismo en estudio se expone de esta manera a un gradiente de concentraciones del aceite esencial alcanzándose la concentración mínima inhibitoria a cierta distancia. Los reservorios para el aceite esencial pueden ser discos de papel filtro (Fig. 2A), cilindros de metal o de vidrio (Fig. 2B), u hoyos realizados en la superficie del agar (Fig. 2C) (Vicente y Peláez 2007). Otra opción es colocar los aceites esenciales en gotas directamente sobre la superficie del medio del cultivo sin utilizar reservorios (Fig. 2D).
El patógeno se incuba a las condiciones ideales para su crecimiento durante el tiempo correspondiente. Para una correcta interpretación de los resultados, siempre deben incluirse controles negativos (sin aceite esencial) y controles positivos (productos con inhibición comprobada sobre el patógeno). Al final del experimento, se observará el crecimiento del microorganismo, excepto en la región donde la concentración de la sustancia está por encima de la concentración mínima inhibitoria (CMI). Allí se observa una zona de inhibición (halo), cuyo tamaño queda determinado por la capacidad de difusión del agen-
114 DESARROLLO SOSTENIBLE
te antimicrobiano y la sensibilidad del microorganismo (Pérez López 2005). Los halos de inhibición se analizan considerando que la inhibición puede ser completa, parcial o producir sobrecrecimiento (Vicente y Peláez 2007).

Figura 2. Métodos de difusión en agar. A: discos de papel de filtro; B: cilindros de vidrio; C: hoyos en el medio agarizado; D= gotas colocadas directamente en el medio agarizado. La placas fueron sembradas con el hongo Penicillium digitatum y los cilindros contienen diferentes aceites esenciales, controles positivo y negativo.
Cuando la inhibición es completa se observa un halo transparente sin la presencia del microorganismo alrededor del sitio donde fue colocado el aceite esencial. En la inhibición parcial, se observa un halo turbio debido al crecimiento del microorganismo, aunque menor que en el tratamiento control. El sobrecrecimiento produce un efecto inverso a la inhibición y se observa un abundante crecimiento.
No debe estimarse el tamaño del halo como una medida cuantitativa de la capacidad de inhibición del aceite esencial. Por ello, no se recomienda utilizar esta técnica para comparar el potencial inhibitorio de los aceites esenciales entre sí. Los aceites esenciales no tienen la misma densidad o tienen distintos grupos hidrofóbicos que le confieren diferente capacidad para difundir en el soporte. Por ejemplo, un aceite esencial con un fuerte poder inhibitorio, pero con bajo coeficiente de difusión en agua, mostrará un pequeño halo a pesar de su potencial para inhibir el desarrollo del microorganismo. La capacidad de volatilización de los aceites esenciales también puede condicionar el tamaño del halo (Janssen et al 1986).
1.1.2 Métodos bioautográficos
El método bioautográfico (Furlán y López 2006) puede considerarse una variante del método de difusión pues comparte sus principios fundamentales y es afectado por los mismos factores. La técnica fue también utilizada para testar compuestos naturales contra hongos fitopatógenos (Hadacek and Greger 2000).
115 DESARROLLO DE ECOFUNGICIDAS
Cuando se evalúan aceites esenciales, la técnica consiste en aplicar una gota del aceite esencial sobre la placa cromatográfica, pero sin realizar posteriormente el desarrollo cromatográfico para la separación de los compuestos. Los aceites esenciales absorbidos en la placa cromatográfica tienen la capacidad de difundir a través de un medio acuoso en el que se ha colocado el microorganismo inhibiendo su desarrollo.
La diferencia con los métodos de difusión descriptos anteriormente es que los compuestos a analizar difunden al medio desde la placa cromatográfica. Según la forma en que se produce el contacto entre el microorganismo y el aceite esencial (placa cromatográfica), Furlán y López (2007) definen tres tipos de bioautografía:
Directa: El microorganismo se coloca directamente sobre la placa cromatográfica (Fig. 3A);
En capa de agar: El microorganismo se incorpora en un medio agarizado que es distribuido sobre la placa cromatográfica donde solidifica (Fig. 3B);
De contacto: La placa cromatográfica se apoya sobre la superficie de un medio agarizado e inoculado y luego es retirada (Fig. 3C).
Las placas se incuban a las condiciones ideales para el crecimiento del patógeno durante el tiempo correspondiente. Para la evaluación de los resultados, se utilizan compuestos que colorean las zonas metabólicamente activas diferenciándolas de las inactivas (incoloras) donde se ha producido la inhibición de los microorganismos.
Cuando la bioautografía se aplica en forma tradicional, separando previamente los compuestos activos de la mezcla desarrollando la cromatografía, se pueden detectar los compuestos activos en la mezcla que conforman el aceite esencial (Choma y Grzelak 2011).



3. Bioautrografia en placa cromatográfica. A) directa; B) en capa de agar; C) de contacto.
116 DESARROLLO SOSTENIBLE
B C
A
Figura
1.2 Segunda etapa
1.2.1 Métodos de dilución
Los métodos de dilución consisten en confrontar distintas concentraciones del compuesto con el microorganismo en estudio para obtener una valoración cuantitativa de su capacidad de inhibición (Derita et al. 2007).
La concentración más baja del aceite esencial que inhibe el crecimiento del microorganismo se conoce como la “concentración mínima inhibitoria” aunque suele abreviarse como MIC por su nombre en inglés (minimal inhibitory concentration). La ausencia de crecimiento se determina por visualización a ojo desnudo (Pauli y Schilcher 2010). Debido a la insolubilidad de los aceites esenciales en agua, para realizar las suspensiones deben de emulsionarse previamente con solventes o detergentes. En las evaluaciones de rutina realizadas en nuestro laboratorio suele utilizarse dimetilsulfóxido (DMSO) como solvente sin superar el 5% del volumen final (Engelmeier y Hadacek 2006). Se debe tener en cuenta que el uso de solventes o detergentes pueden influenciar el resultado (Hill et al. 1997). Cuando los resultados se comparan entre laboratorios, se debe recordar además que los medios de cultivo y las condiciones del experimento pueden influenciar en el resultado. En nuestro laboratorio se han tomado como base los protocolos sugeridos por el Clinical and Laboratory Standards Institute (2002) con modificaciones (Engelmeier y Hadacek 2006). Se describirán los métodos de microdilución en medio sólido y medio líquido que son los que hemos aplicado en nuestros trabajos de investigación. Los métodos de microdilución son adaptaciones realizadas de los métodos de macrodilución, que permiten disminuir los costos y hacen posible realizar en forma simultánea la evaluación de un número mayor de aceites esenciales.
Microdilución en medio sólido: Este método es una adaptación del procedimiento que aplicamos anteriormente para evaluar la resistencia de P. digitatum a fungicida imazalil (Pérez et al. 2011). Los ensayos fueron implementados en placas de poliestireno de 24 pocillos. Un volumen establecido de medio de cultivo agarizado a una temperatura máxima de 37°C, ya que contiene diluciones seriadas del aceite esencial volátil, es incorporado en los pocillos de la placa. En una de las columnas, el aceite esencial se sustituye por un producto biocida conocido (control +) y en otra columna por el solvente utilizado (control -) (Fig. 4A).
Luego que el medio de cultivo se solidifica, se procede a inocular el microorganismo en estudio, colocando en cada pocillo sobre la superficie del medio de cultivo una microgota (20 µL) de una suspensión de concentración conocida. Las placas se incuban en condiciones de luz y temperatura adecuadas. La evaluación se realiza mediante la observación visual de la presencia/ ausencia del microorganismo. Como el aceite esencial puede volatilizarse, durante el tiempo de incubación las placas se colocan en cámara húmeda para asegurar una atmósfera adecuada al crecimiento.
117 DESARROLLO DE ECOFUNGICIDAS
Microdilución en medio líquido: Esta técnica fue desarrollada para evaluar la eficacia de aceites esenciales sobre Penicillium italicum, P. digitatum y Colletotrichum musea por Kouasii et al. (2012). Se utilizan placas de 96 pocillos. Suele utilizarse en cada pocillo, entre 50 y 100 mm3 del medio de cultivo con la solución del aceite esencial a testar diluida en forma seriada. En cada pocillo, menos en la columna control, se agrega el mismo volumen de la suspensión del patógeno a testar con concentración conocida. Una columna de la placa es utilizada como control negativo (sin aceite esencial incorporado).
Las placas son incubadas en cámara húmeda a las condiciones ideales para el crecimiento del patógeno durante el tiempo correspondiente. En algunos casos, generalmente cuando el patógeno es de origen bacteriano, p. ej. Xanthomonas vesicatoria, el cambio en la turbidez puede ser medida utilizando un espectrofotómetro mediante el porcentaje de transmisión o absorción de la luz que pasa por los pocillos a una determinada longitud de onda. Para ello, deben incluirse blancos que permitan realizar correcciones de los valores medidos ocasionados por la diferente coloración que otorga el aceite esencial utilizado en diferentes concentraciones (Fig. 4B).
Otra forma de observación del crecimiento es utilizar colorantes vitales con el mismo fundamento explicado para las técnicas bioautográficas. En el caso de los hongos que producen esporas coloreadas, se puede realizar una evaluación visual a ojo desnudo observando presencia/ausencia del patógeno.


Figura 4. Determinación de la mínima concentración inhibitoria del aceite esencial de Baccharis trimera sobre Xanthomonas vesicatoria. A) Método de microdilución en medio sólido utilizando placas de 24 pocillos, B) Método de microdilución en medio liquido en placas de 96 pocillos, mediante tinción con colorante tetrazolio (2.5%).
1.2.2 Evaluación del efecto de los aceites esenciales en fase vapor Teniendo en cuenta que los aceites esenciales son mezcla de compuestos volátiles, el test de fase vapor permite conocer el potencial de aplicación
118 DESARROLLO SOSTENIBLE
Control + 1000ppm 500ppm 250ppm 125 ppm ControlA B 1000ppm 500ppm 250pm 125ppm 62ppm 31ppm 16ppm 8ppm 4ppm 2ppm Control- Control +
en fase vapor (como fumígenos o fumigantes). El procedimiento es sencillo y consiste en exponer al microorganismo a los efectos de los compuestos volátiles evitando el contacto directo (Matsouka et al. 1990).
Evaluaciones con aceites esenciales fueron realizadas tempranamente por Inouye et al. (2000). La técnica conocida como “tapa invertida” es simple, económica y los resultados son fácilmente observados. Consiste en sembrar el microorganismo en un medio de cultivo agarizado vertido sobre una tapa de una caja de Petri estéril (puede ser por inclusión o en superficie) y colocar sobre la otra tapa el aceite esencial directamente sobre el vidrio o sobre un soporte (por ejemplo, papel de filtro o portaobjeto). Luego, ambas tapas se enfrentan y se sellan con film adherente para evitar la volatilización del aceite esencial (Fig. 5).


Figura 5. A) Técnica de la “tapa invertida”. B) Observación de los resultados luego de un período de incubación de las placas en condiciones de luz y temperatura ideal para el crecimiento del hongo.
1.2.3 Efecto biocida o bioestático
La ausencia de crecimiento que se observa a ojo desnudo no significa que el efecto del aceite esencial sobre el patógeno sea letal (efecto biocida). Muchas veces los aceites esenciales detienen el crecimiento del microorganismo (efecto bioestático) y al interrumpir el contacto entre ellos, el microorganismo comienza a crecer.
Las pruebas para evaluar el efecto biocida/bioestático consisten en tomar muestras del patógeno de aquellos recipientes donde no ha crecido y colocarlos en las mismas condiciones de crecimiento, pero en ausencia del aceite esencial. Es un método clásico recomendado en la evaluación de fungicidas de síntesis (Dhingra y Sinclair 1995).
Luego de incubadas las placas, se evalúa en forma visual si hay alguna evolución en el crecimiento del patógeno. Cuando la muestra proviene de la inoculación de esporas de hongos en medio líquido y se tiene mucho entrenamiento en la observación microscópica de esporas, puede observarse directamente el aspecto de estas realizando un preparado directo. La observación de
119 DESARROLLO DE ECOFUNGICIDAS
A B
la alteración en el tubo germinativo o en el aspecto de las esporas puede ser suficiente para determinar la actividad biocida.
1.2.4 Evaluación in vitro de aceites esenciales sobre parásitos obligados Los procedimientos presentados anteriormente pueden ser empleados para patógenos de planta capaces de sobrevivir y reproducirse sin estar en contacto con el tejido del hospedero. Podosphaera aphanis, agente causal de oídio en frutilla, es un patógeno obligado y por tanto no es viable realizar experimentos in vitro sin la presencia del tejido vegetal que parasita. Por tanto, en nuestro laboratorio, se ajustó una metodología con la finalidad de poder realizar el tamizado eficiente de varios aceites esenciales en forma similar a los ensayos realizados para parásitos y saprófitos facultativos. Se evaluó el efecto sobre la germinación de esporas o conidios.
Se prepararon discos vegetales a partir de hojas en expansión (aproximadamente 2/3 del tamaño final) extraídas de plantas de frutilla creciendo en condiciones de caja de vegetación y aisladas del patógeno. En el laboratorio, las hojas fueron lavadas suavemente en agua de grifo, desinfectadas durante 1 min con hipoclorito de sodio (0.1% v/v) y enjuagadas para eliminar los residuos del desinfectante. Luego se mantuvieron en cámara de flujo hasta que no se observó la presencia de agua libre sobre las mismas (aproximadamente 1 h).
Los aceites esenciales fueron aplicados en 6 a 8 foliolos por tratamiento utilizando un aspersor para cromatografía. Las suspensiones fueron realizadas en agua, emulsionando previamente el aceite esencial en dimetilsulfóxido (DMSO), no sobrepasando el 5% del volumen final. Las hojas permanecieron en cámara de flujo laminar hasta que no se observó agua libre sobre las mismas (aprox. 30-45 min). Luego, entre 10 y 20 discos de 10 mm de diámetro fueron cortados con el auxilio de un sacabocado y colocados en placas de Petri conteniendo una capa de aprox. 5 mm de agua agarizada al 18% (Fig. 6A).
El inóculo se obtuvo a partir de plantas de frutilla infectadas creciendo en invernáculo con condiciones predisponentes para la enfermedad. Se cosecharon hojas con infecciones incipientes (observación de signo no mayor a 7 días) y las áreas infectadas fueron colocadas en tubos con tensoactivo Triton™ X-100 (Merck, 0.01% v/v). Los tubos fueron agitados durante 30 s, y en condiciones asépticas la suspensión fue filtrada usando dos capas de liencillo estéril. La concentración de conidios fue ajustada con cámara de Neubauer a 105 conidia/cm3 . Los discos de hoja fueron inoculados uniformemente por aspersión y las placas se mantuvieron abiertas en condiciones de asepsia durante 24 h para favorecer el proceso de secado de las hojas. Los tratamientos control fueron asperjados con Triton™ X-100 (0.01% v/v) con y sin DMSO.
Es importante el correcto secado de la hoja porque la germinación de las esporas de P. aphanis se ven afectada por el agua libre. Las placas fueron incubadas durante 48 h con luz diurna y temperatura controlada a 20°C ± 1 cuando se procedió a la evaluación.
120 DESARROLLO SOSTENIBLE



Figura 6. Evaluación del efecto de aceites esenciales en el control de oídio (Podosphaera aphanis) en frutilla. A) Acondicionamiento de los discos en placas de Petri para ser inoculados con el hongo, B) discos de hojas clarificados, C) observación microscópica de conidios germinados y sin germinar sobre los discos de hoja (aumento 40x).
Con esta metodología se obtuvo un 50 a 60% de conidios germinados en los tratamientos control y no hubo efecto del DMSO sobre el patógeno. Para evaluar la germinación de los conidios se siguió el procedimiento descrito por Stadnik y Buchenauer (2000). Se midieron 100 esporas al azar por disco de hojas clarificados (Fig. 6B), considerando una germinación exitosa cuando el tamaño del tubo germinativo excedió el ancho del conidio (Fig. 6C). Finalmente, los resultados fueron comparados con el tratamiento control sin aceite esencial.
2. ENSAYOS IN VIVO
Existen muchas referencias bibliográficas que mediante pruebas in vitro demuestran la presencia en plantas de compuestos con efecto biocida o biostático (Shaaban et al. 2012) e inclusive, algunos de los compuestos han sido identificados (Zaker 2016) y hasta sintetizados (Wypych y Wypych 2015). Sin embargo, un menor número de investigaciones demuestran que el efecto en el control se mantiene cuando la planta hospedero es tenida en cuenta. Nuestros ensayos en vivo evaluaron aquellos aceites esenciales que in vitro habían demostrado resultados promisorios para el control de patógenos que causan enfermedades en poscosecha en fruta cítrica y en arándanos. A continuación, se detallan los procedimientos utilizados para evaluar el control de Alternaria tenuissima en arándanos (Umpierrez et al . 2014) y de Phyllocticta citricarpa en frutos de naranja Valencia (Lombardo et al. 2016).
2.1 Control de Alternaria tenuissima en frutos de arándanos
Una de las características apreciadas en la calidad de los frutos de arándanos es el aspecto que le confiere la presencia de pruínas naturales. Por
121 DESARROLLO DE ECOFUNGICIDAS A B C
ello, en el proceso de cosecha y poscosecha la manipulación de la fruta se realiza con especial cuidado para conservar el atractivo natural.
Los experimentos realizados estuvieron orientados a conocer la viabilidad de utilizar aceites esenciales para el control poscosecha de Alternaria tenuissima en frutos que son envasados y transportados en contenedores cerrados a mercados de ultramar (larga distancia).
Se utilizó la técnica de la “tapa invertida” utilizando dos tapas de 15 mm de altura de placas de Petri de 90 mm de diámetro. Los frutos de arándano fueron inoculados en la herida de la inserción del pedúnculo con 20 µL de una suspensión de esporas de 1x103 ufc/cm3 (Fig. 7A). Se utilizó un aislamiento de Alternaria tenuissima obtenido de frutos contaminados y aceites esenciales extraidos de hojas de Lippia alba, Baccharis trimera, Schinus molle y Ocimum selloi.
Los aceites esenciales fueron colocados a razón de 1% (p/v) sobre papel de filtro adherido a la cara interna de la tapa de la placa de Petri a 0.5 mm de distancia de la fruta. Los controles fueron frutas inoculadas sin exposición al aceite esencial. Las tapas fueron selladas con Parafilm® e incubadas a 27°C durante 7 días (Fig. 7B) cuando se evaluó la incidencia de la enfermedad. Se realizaron 3 repeticiones de 10 frutos cada una por cada tratamiento.

A B

Figura 7. Determinación del efecto de la fase volátil de un aceite esencial en frutos de arándanos inoculados con Alternaria tenuissima. A) frutos inoculados; B) frutos inoculados y expuestos a la fase volátil del aceite esencial.
2.2 Control de la esporulación de Phyllosticta citricarpa sobre frutos cítricos La mancha negra de los cítricos es una enfermedad que provoca lesiones en frutos y sobre las mismas se producen estructuras de reproducción asexual (picnidios) del hongo. Las picnidiosporas son liberadas cubiertas por
122 DESARROLLO SOSTENIBLE
una masa gelatinosa y se dispersan sólo a corta distancia cuando el fruto se moja y el agua es capaz de salpicar. Por ello, la dispersión a larga distancia a través del fruto es considerada de bajo riesgo.
Sin embargo, algunos países donde la enfermedad no está presente, prohíben el ingreso de fruto con lesiones de la enfermedad. Si se logra inhibir el desarrollo del patógeno sobre las lesiones, no existe riesgo alguno de dispersión de la enfermedad por frutos contaminados.
Se evaluó el efecto del aceite esencial de Chenopodium ambrosioides que había demostrado ser 100% efectivo in vitro (Lombardo, 2016). Se utilizaron frutos de naranja Valencia y limón con síntomas de la enfermedad. Los Frutos fueron cosechados y observados cuidadosamente con una lupa 20X (Fig. 8A) seleccionando en cada fruto lesiones de mancha dura sin estructuras reproductivas. Con el auxilio de un sacabocado de 8 mm de diámetro, las lesiones fueron retiradas (Fig. 8B) y los discos obtenidos fueron superficialmente esterilizados y secados en papel de filtro (Fig. 8C).


A B C

Figura 8. Procedimiento utilizado para identificar y obtener lesiones sin estructuras reproductivas y del tipo mancha dura de la enfermedad mancha negra de los cítricos. A ) Identificación de las lesiones con las características de interés utilizando una lupa 20X, B) extracción de las lesiones que previamente fueron marcados con el auxilio de un sacabocado, C) discos de frutos de naranja Valencia con lesiones de mancha dura sin estructuras reproductivas visibles.
Para evaluar el efecto fungicida en fase líquida, una gota de 0.01 cm3 de aceite esencial puro fue colocado sobre cada lesión, mientras que para conocer el efecto de la fase vapor, el aceite esencial (0.1% (p/v)) fue colocado sobre un cubreobjeto apoyado en la superficie del agar. Los controles para ambas evaluaciones fueron tratados de idéntica manera sin exponerlos al efecto del aceite esencial. Las placas fueron selladas y se mantuvieron a 25°C y ciclo de 16 h de luz y 8 h de oscuridad. Se realizaron 3 repeticiones por tratamiento. A los
123 DESARROLLO DE ECOFUNGICIDAS
7 días se evaluó la presencia de estructuras reproductivas y cuando presentes, se realizó una cuantificación de conidios usando una cámara de Neubauer. Para preparar la suspensión de esporas, los discos individualmente fueron colocados en tubos de vidrio conteniendo 5 cm3 de agua tritonada (Triton™ X-100 (0.01% v/v) que se agitaron por 2 min en Vortex.
3. CARACTERIZACIÓN QUÍMICA DE LOS ACEITES ESENCIALES
La técnica más utilizada para obtener los aceites esenciales es la destilación por arrastre con vapor de agua (Elder 2010). Los tres tipos básicos de destilación de aceites esenciales son la hidrodestilación, la destilación mixta y la destilación por arrastre con vapor. Los tres tipos hacen referencia al contacto del material vegetal con el agua líquida y/o vapor.
El diseño básico de un destilador incluye el tanque de destilación, que varía según el tipo de destilación, a la salida del tanque, un tubo cuyo diámetro disminuye (cuello de cisne) va conectado al condensador. El producto de la condensación es colectado por el vaso florentino, donde el agua se separa de los aceites esenciales y luego son recuperados.
La producción de plantas aromáticas y aceites esenciales es afectada por diversos factores, como:
Material vegetal: La selección de variedades y factores externos (nutrientes, agua, intensidad lumínica, temperatura, entre otros) afectan el rendimiento y la composición de los aceites esenciales en una determinada planta aromática;
Procesamiento y destilación de los aceites esenciales: La época de cosecha, estado vegetativo de las plantas, cosecha y tratamiento poscosecha, tipo destilación, materiales utilizados para la destilación y almacenamiento de los aceites esenciales afectan la calidad de los aceites esenciales obtenidos (caracteres sensoriales, físicos y químicos) requerida.
En consecuencia, el análisis y control de los aceites esenciales constituyen pasos imprescindibles que debe efectuarse previamente a la utilización de los mismos en un proceso industrial. Su realización responde a la necesidad de asegurar su identidad y garantizar su pureza (Garay 2010). Para definir una estrategia analítica que considere los elementos que se han mencionado, debemos partir del hecho que los aceites esenciales generalmente son mezclas complejas de hasta más de cien componentes, que pueden tener la siguiente naturaleza química: Compuestos alifáticos de bajo peso molecular (alcanos, alcoholes,aldehídos, cetonas, ésteres y ácidos); Monoterpenos (oxigenados o no); Sesquiterpenos (oxigenados o no); Fenilpropanoides. En este sentido, se han recogido una serie de estándares y especificaciones en documentos oficiales como farmacopeas, normas ISO, de la Essential Oil Association, de la American Spice Trade Organization (ASTA), y otros. En la actualidad, la implantación de métodos instrumentales de análisis, principal-
124 DESARROLLO SOSTENIBLE
mente cromatográficos y espectroscópicos, que son más rápidos, completos y sensibles, ha ido restringiendo la utilización de los índices químicos. Esta situación es consecuencia de que estos métodos son aceptados universalmente, efectivos y de rápida aplicación. En este sentido, en el caso de mezclas más complejas se prefiere la aplicación de métodos espectroscópicos del tipo infrarrojo (IR) e infrarrojo cercano (NIR).
Sin embargo, es indudable que la mayor parte de los análisis realizados en el marco del control de calidad de los aceites esenciales utiliza diferentes técnicas cromatográficas como es el caso de la cromatografía en capa fina (TLC), cromatografía gaseosa (GC) y cromatografía líquida de alta presión (HPLC) (Dellacasa y Bandoni 2011). También son utilizadas otras técnicas espectroscópicas, además de las mencionadas, como es el caso de espectroscopia ultravioleta (UV), espectroscopia de absorción atómica (AA), la resonancia magnética nuclear (1H-NMR, 13C-NMR) y la espectroscopia de masa (MS). Finalmente, más recientemente han adquirido mayor importancia las configuraciones que utilizan sistemas acoplados donde se aprovecha la capacidad de separación de un sistema cromatográfico con el potencial de elucidación estructural que ofrece un método espectroscópico, como el caso de GC-MS, GC-IFTR y HPLC-MS (Dugo et al. 2002, Chin y Marriot 2014).
C ONSIDE r ACIONES FINALES
La eliminación o reducción del uso de fungicidas sintéticos para el control de enfermedades en las plantas cultivadas es un requerimiento para disminuir los efectos adversos que producen sobre la salud humana y el medio ambiente. A corto plazo, una opción viable es realizar tratamientos utilizando sustancias de baja o nula toxicidad con acción sinérgica con los fungicidas de síntesis tradicionales para reducir significativamente las dosis de los productos nocivos en los tratamientos fitosanitarios, disminuyendo de este modo la toxicidad y residuos.
En este trabajo se ha presentado un ejemplo de esta estrategia que involucra el uso de aceites esenciales. Las diferentes metodologías requeridas para verificar un uso eficiente y seguro de estos productos muestran las etapas a mediano y largo plazo, infraestructura necesaria, pero fundamentalmente la necesidad trabajar con formaciones complementarias y el involucramiento de los productores.
REFERENCIAS BIBLIOGRÁFICAS
Abd-AllA M et al. (2011) Evaluation of lemongrass, thyme and peracetic acid against gray mold of strawberry fruits. Journal of Agricultural Science and Technology, 7(6):1775-1787.
125 DESARROLLO DE ECOFUNGICIDAS
Al-Samarrai G, Singh H, Syarhabil M (2012) Evaluating eco-friendly botanicals (natural plant extracts) as alternatives to synthetic fungicides. Annals of Agricultural and Environmental Medicine, 9:673-676.
Alilou HA, Akssira MO, Hassani L, Chebli B, Hak A (2008) Chemical composition and antifungal activity of Bubonium imbricatum volatile oil. Phytopathologia Mediterranea, 47:3-10.
Antignac E, Nohynek GJ, Re T, Clouzeau J, Toutain H (2011) Safety of botanical ingredients in personal care products/cosmetics. Food and Chemical Toxicology, 49(2):324-341. doi.org/10.1016/j.fct.2010.11.022.
Araújo CP et al. (2010) Acaricidal activity against Tetranychus urticae and chemical composition of peel essential oils of three Citrus species cultivated in NE Brazil. Natural Product Communications, 5(3):471-476.
Badawy IFM, Nashwa Sallam MA, Ibrahim AR, Asran MR (2011) Efficacy of some essential oils on controlling green mold of orange and their effects on postharvest quality parameters. Plant Pathology Journal, 10(4):168-174. doi.org/10.3923/ppj.2011.168.174.
Bagetta G, Cosentino M, Sakurada T (2016) Aromatherapy. basic mechanisms and evidence-based clinical use. Taylor and Francis Group, LLC. Boca Raton, FL, 461p.
Bakkali F, Averbeck S, Averbeck D, Idaomar M (2008) Biological effects of essential oils. A review. Food Chem Toxicol, 46(2):446-475. doi.org/10.1016/j. fct.2007.09.106.
Bedmar F (2011) ¿Qué son los plaguicidas agrícolas? Ciencia Hoy, 21:11-16. http://www.cienciahoy.org.ar/ch/ln/hoy122/plaguicida1.htm. Acceso Marzo 2019.
Borges DF et al. (2018) Formulation of botanicals for the control of plant-pathogens: A review. Crop Protection, 110:135-140. doi.org/10.1016/j.cropro.2018.04.003.
Burkey JL, Sauer JM, McQueen CA, Sipes IG (2000) Cytotoxicity and genotoxicity of methyleugenol and related congeners – a mechanism of activation for methyleugenol. Mutation Researcj, 453(1):25-33. doi.org/10.1016/S00275107(00)00070-1.
Calo JR, Crandall PG, O’Bryan CA, Ricke SC (2015) Essential oils as antimicrobial in food systems: a review. Food Control, 54:111–119. doi:10.1016/j.foodcont.2014.12.040
Chin ST, Marriott PJ (2014) Multidimensional gas chromatography beyond simple volatiles separation. Chemical Communications, 50(64):8819-8833.
Choma IM, Grzelak EM (2011) Bioautography detection in thin-layer chromatography. Journal of Chromatography A , 1218(19):2684-2691. doi:10.1016/j. chroma.2010.12.069.
Chouhan S, Sharma K, Guleria S (2017) Antimicrobial activity of some essential oils-present status and future perspectives. Medicines, 4(3):1-21. doi:10.3390/medicines4030058.
126 DESARROLLO SOSTENIBLE
National Comitee for Clinical and Laboratory Standards (2002) Reference method for broth dilution antifungal susceptibility testing of filamentous fungi, approved standard-M38_A. Clinical and Laboratory Standards Institute. Wayne, PA, 49p.
De Bary A (1861) Ueber die Geschlechtsorgane von Peronospora. Botanische Zeitung, 19:89-91.
Dellacassa E, Bandoni A (2011) El control de calidad en la industria de los aceites esenciales. En: Zygadlo J (ed) Aceites Esenciales. Química, Ecología, Comercio, Producción y Salud. Universitas, Editorial Científica Universitaria, Córdoba, A, pp.143-164.
Derita M, Castelli MV, Sortino M (2007) Método de dilución en agar. In: Manual de técnicas in vitro para la detección de compuestos antifúngicos. Zachino S and Gupta M (eds) Corpus Rosario, pp.75-84.
Dhingra OB, Sinclair JB (1995) Fungicide evaluation. In: Basic Plant Pathology Methods. 2nd Edition, CRC Press, Boca Raton, pp.267-283.
Dixit SN, Chandra H, Tiwari R, Dixit V (1995) Development of a botanical fungicide against blue mold of mandarins. Journal of Stored Products Research, 31(2): 165-172. doi.org/10.1016/0022-474X(94)00041-Q.
Dugo G, Dugo P, Mondello L (2002) Multidimensional chromatography: foods, flavours and fragrances applications. In: Mondello L, Lewis AC, Bartle KD. Multidimensional Chromatography. John Wiley and Sons Ltd., Chichester, pp.217-250.
Elder H (2010) Optimización de Procesos Extractivos aplicados a especies vegetales aromáticas y medicinales. Buenas prácticas de operaciones unitarias. In: Dellacassa E (Ed.). Normalización de productos naturales obtenidos de especies de la flora aromática latinoamericana: proyecto CYTED IV.20, EDIPUCRS, Porto Alegre, pp.37.
Engelmeier D, Hadecek F (2006) Antifungal natural products: assays and applications. In Mahendra R and Carpinella C (eds) Advances in Phytomedicine. Naturally occuring bioactive compounds, v. 3, Elsevier B.V.
Furlán R, López S (2006) Métodos bioautográficos. In: Manual de técnicas in vitro para la detección de compuestos antifúngicos, Corpus Rosario, pp.5769.
Garay R (2010) Sistemas de normalización y sus beneficios en el desarrollo del sector de las plantas aromáticas y sus derivados. En: E. Dellacassa (Ed.). Normalización de productos naturales obtenidos de especies de la Flora Aromática Latinoamericana. Proyecto CYTED IV.20. EDIPUCRS, Porto Alegre, pp.301-310.
García-Roche M (2014) Aplicación de aceites esenciales para el control de bacteriosis que afectan la producción de Solanum lycospersicum L. (tomate). Disertación, Universidad ORT, Uruguay.
Gianessi LP, Reigner N (2006) The importance of fungicides in U.S. crop production. Outlooks on Pest Management, 17(5):209-213.
127 DESARROLLO DE ECOFUNGICIDAS
Helander I et al. (1998) Characterization of the action of selected essential oil components on Gram-negative bacteria. Journal of Agricultural and Food Chemistry, 46(9):3590-3595.
Hadacek F, Greger H (2000) Testing of antifungal natural products: methodologies, comparability of results and assay choice. Phytochemical Analysis, 11(3):137-147.
Hill P, Evans CS, Veness RG (1997) Antimicrobial action of essential oils: the effect of dimethylsulphoxide on the activity of cinnamon oil. Letters in Applied Microbiology, 24(4):269-275.
Inouye S et al. (2000) Inhibitory effect of essential oils on apical growth of Aspergillus fumigatus by vapour contact. Mycoses, 43(1-2):17-23. doi.org/10.1046/j.1439-0507.2000.00538.x.
Isman MB, Miresmailli S, Machial C (2011) Commercial opportunities for pesticides based on plant essential oils in agriculture, industry and consumer products. Phytochemistry Review, 10(2):197-204. doi.org/10.1007/s11101010-9170-4.
Janssen AM et al. (1986) Screening for antimicrobial activity of some essential oils by the agar overlay technique. International Journal of Clinical Pharmacy, 8(6):289-292.
Khaledi N, Taheri P, Tarighi S (2015) Antifungal activity of various essential oils against Rhizoctonia solani and Macrophomina phaseolina as major bean pathogens. Journal of Applied Microbiology, 118(3):704-717. doi. org/10.1111/jam.12730.
Klieber AA, Scott EB, Wuryatmo EA (2002) Effect of method of application on antifungal efficacy of citral against postharvest spoilage fungi of citrus in culture. Australasian Plant Pathology, 31(4):329-332.
Kouassi KH, Bajji M, Zhiri A, Lepoivre P, Jijakli MH (2010) Evaluation of three essential oils as potential sources of botanical fungicides. Communications in agricultural and applied biological sciences, 75(4):525-529.
Kouassi HS et al. (2012) Development and application of a microplate method to evaluate the efficacy of essential oils against Penicillium and Colletotrichum musea (Berk. & MA Curtis ) Arx, three postharvest fungal pathogens of fruits. Biotechnology, Agronomy, Society and Environment, 16(3):325–336.
Lombardo P, Guimaraens A, Franco J, Dellacassa E, Pérez E (2016) Effectiveness of essential oils for postharvest control of Phyllosticta citricarpa (citrus black spot) on citrus fruit. Postharvest Biololgy Technology, 121:1–8.
López A et al. (2014) Insecticidal activity of microencapsulated Schinus molle essential oil. Industrial Crops and Products, 53: 209-216. doi:10.1016/j.indcrop.2013.12.038.
Matsouka H, Li Y, Takekawa Y, Teraoka T (1990) Evaluation of antifungal volatile compounds on the basis of the elongation rate of a single hypha. Applied and Environmental Microbiology, 56(12):3779-3784.
128 DESARROLLO SOSTENIBLE
Mc Callan SEA (1967) History of fungicides. In: Fungicides. An Advanced Treatise. Vol. 1, Agricultural and Industrial Applications, Environmental Interactions. Dewayne C. Torgeson (ed) Academic Press, London, pp.1-29.
Pauli A, Schilcher H (2010) In vitro antimicrobial activities of essential oils monographed in the European Pharmacopoeia 6th Edition. In: Handbook of essential oils: science, technology, and applications. CRC Press Boca Raton, FL, pp.353–548.
Pérez E et al. (2011) Postharvest Biology and Technology Imazalil concentration for in vitro monitoring of imazalil resistant isolates of Penicillium digitatum in citrus packinghouses. Postharvest Biology Technology, 60:258–262.
Pérez López AL (2005) Aislamiento y caracterización de compuestos de plantas del noreste de México con actividad contra cepas de Streptococcus pseumoniae, Staphilococcus aureus y Haemophicus influenze Dissertation, Universidad Autónoma de Nuevo Leon.
Qayumi S (2007) Macro and Microdilution Methods of Antimicrobial Susceptibility Testing Antimicriobial susceptibility testing protocols. In: Antimicrobial susceptibility testing protocols. Boca Ratón (Florida): Taylor and Francis Group, pp.75-80.
Rabbinge R, Oijen Van M (1997) Scenario studies for future agriculture and crop protection. European Journal of Plant Pathology, 103(3):197–201.
Shaaban HA, El-Ghorab AH (2012) Bioactivity of essential oils and their volatile aroma components, Journal of Essential Oil Research, 24(2):203-212.
Stenersen J (2004) Chemical pesticides mode of action and toxicology. CRC Press, Boca Raton, FL, 296p.
Stadnik MJ, Buchenauer H (2000) Inhibition of phenylalanine ammonia-lyase suppresses the resistance induced by benzothiadiazole in wheat to Blumeria graminis f. sp. tritici. Physiological and Molecular Plant Pathology, 57(1):25-34.
Wypych A, Wypych G (2015) Databook of biocides. ChemTech Publishing, Toronto, 446p.
Smith BJ, Wedge DE, Pace PF (2013) A Microtiter Assay Shows Effectiveness of Fungicides for Control of Colletotrichum spp. from Strawberry. International Journal of Fruit Science, 13:205–216.
Tullio V et al. (2007) Antifungal activity of essential oils against filamentous fungi determined by broth microdilution and vapour contact methods. Journal of Applied Microbiology, 102(6):1544-1550.
Umpierrez N et al. (2014) El aceite esencial de Lippia alba como ecofungicida para el control de Alternaria tenuissima en arádanos. IV Jornadas Nacionales de Plantas Aromáticas Nativas y sus Aceites Esenciales. Tucumán, Argentina.
Umpierrez N (2016) Evaluación de la actividad antifúngica de metabolitos presentes en plantas aromáticas nativas para el control de patógenos de cítricos. Disertación, Universidad de la República.
129 DESARROLLO DE ECOFUNGICIDAS
Vicente M, Peláez F (2007) Método de difusión. In: Zachino S and Gupta M (eds), Manual de técnicas in vitro para la detección de compuestos antifúngicos. Corpus Rosario, pp.49-55.
Wanger A (2007) Disk diffusion test and gradient methodologies, In: Schwalbe R, Steele-Moore L, Goodwin AC (eds). Antimicrobial susceptibility testing protocols. Taylor and Francis Group, Abingdon, pp.53-74. doi. org/10.1201/9781420014495.ch3.
Zaker M (2016) Natural plant products as eco-friendly fungicides for plant diseases control- a review. The Agriculturists, 14(1):134-141. doi.org/ doi:10.3329/agric.v14i1.29111.
Zygadlo JA (2011) Los aceites esenciales. Aspectos básicos de su química y biosíntesis. Composición de los aceites esenciales de plantas aromáticas argentinas. En: Aceites Esenciales. Química, Ecología, Comercio, Producción y Salud. Universitas, Editorial Científica Universitaria, Córdoba, pp.143-164.
130 DESARROLLO SOSTENIBLE
SISTEMAS AGROFORESTALES y SILVOPASTORILES
Mónica Dorado 1,2, Mónica Arias 3 , Marcos Sánchez1
1 Universidad Nacional de Córdoba (UNC), Facultad de Ciencias Agropecuarias-. Av. Valparaiso esq. Félix Marrone, Ciudad Universitaria, (5000) Córdoba, Argentina, E-mail: mdorado@agro. unc.edu.ar
2 Universidad Nacional de La Rioja (UNLaR), Departamento Académico Aplicadas, Ciencias y Tecnologías Aplicadas al Ambiente, a la Producción y al Urbanismo, Sede Chamical–Castro Barros 557, (5380) La Rioja, Argentina. E-mail: foresdor@yahoo.com
3 Universidad Católica de Córdoba (UCC), Facultad de Agronomía y Veterinaria-Campus Universitario, Av. Armada Argentina 3555, (5017) Córdoba, Argentina. E-mail monicarias57@ gmail.com
INTRODUCCIÓN
Dada la heterogeneidad de ecosistemas naturales y sistemas agropecuarios y la naturaleza diferenciada de la pobreza rural en América Latina, no existe un tipo único de intervención para el desarrollo: las soluciones deben diseñarse de acuerdo a las necesidades y aspiraciones de la comunidad, así como a las condiciones biofísicas y socioeconómicas de la región. El problema con los enfoques agrícolas convencionales es que no toman en cuenta las variaciones en la ecología, presiones de población, relaciones económicas y organizaciones sociales que existen en la región y por consiguiente el desarrollo agropecuario no estuvo acorde de necesidades y potencialidades de los productores rurales locales.
La totalidad de la revolución tecnológica ha favorecido preferentemente al sector agrícola comercial de gran escala y no a la gran masa de pequeños productores, así como la problemática contemporánea de producción ha evolucionado de una dimensión solamente técnica a dimensiones más sociales, económicas, políticas, culturales y ambientales. La preocupación central en la actualidad es la sustentabilidad agropecuaria. Este concepto, es útil porque incluye un conjunto de preocupaciones en relación a la agricultura concebida como un sistema económico, social y ecológico. La comprensión de estos tópicos más amplios sobre agricultura requiere entender que el desarrollo rural depende de la interacción de los subsistemas biofísicos, técnicos y socioeconómicos a nivel global.
A nivel mundial, está emergiendo en forma creciente, un consenso de que se necesitan nuevas estrategias de desarrollo agropecuario para asegurar
Stadnik MJ, Velho AC, Zorrilla SE (eds.) Desarrollo Sostenible en la Producción Agroalimentaria
131
8
una producción estable de alimentos consecuente con la calidad ambiental. Se prevén los siguientes objetivos:
• Garantizar la seguridad alimentaria;
• Erradicar la pobreza;
• Conservar y proteger el ambiente y los recursos naturales;
• Optimizar el uso de recursos productivos;
• Preservar la cultura local y la pequeña propiedad;
• Asistir y acompañar a los más pobres propiciando procesos de autogestión y de participación comunitaria.
Es claro que no es posible lograr simultáneamente todos estos objetivos en todos los proyectos de desarrollo rural. Existen intercambios entre los distintos objetivos ya que no es fácil obtener a la vez alta productividad, estabilidad y equidad. Los sistemas productivos no existen aislados, ya que pueden ser afectados tanto por mercados nacionales e internacionales o por cambios climáticos (sequías, inundaciones, etc.). Por lo que los problemas productivos de cada sistema son altamente específicos de cada lugar y por lo tanto requieren de soluciones específicas. El desafío es mantener una flexibilidad suficiente que permita la adaptación a cambios ambientales y socio-económicos impuestos desde afuera.
Los elementos básicos de un sistema sustentable son la conservación de los recursos renovables, la adaptación del objetivo de producción al medio ambiente y el mantenimiento de niveles moderados pero sustentables de productividad. Para garantizar la sustentabilidad ecológica de largo plazo en lugar de la productividad de corto plazo, el sistema de producción debe:
• Reducir el uso de energía y recursos y regular la inversión total de energía;
• Reducir las pérdidas de nutrientes del suelo, mejorar el reciclado de nutrientes;
• Estimular la producción de genotipos adaptados al conjunto natural y socio-económico;
• Sustentar la producción neta deseada mediante la preservación de los recursos naturales;
• Reducir los costos y aumentar la eficiencia y viabilidad económica de los pequeños y medianos productores, promoviendo un sistema diverso y flexible.
1. INDICADORES DE SOSTENIBILIDAD
Un método de análisis y desarrollo tecnológico se debe concentrar en la productividad, y también en otros indicadores del comportamiento del agroecosistema, tales como la estabilidad, la sustentabilidad, la equidad y la relación entre estos.
132 DESARROLLO SOSTENIBLE
La sustentabilidad es la medida de un sistema para mantener la producción a través del tiempo, en presencia de repetidas restricciones ecológicas y presiones socio-económicas (Altieri 1988).
La equidad supone medir el grado de uniformidad con que son distribuidos los productos del agroecosistema entre los productores y consumidores locales (Altieri 1988). Esta considera mucho más elementos que ingresos adecuados, buena nutrición o tiempo suficiente para el esparcimiento. Muchos aspectos de la equidad no son fácilmente medibles en términos científicos. Para algunos la equidad se ha alcanzado cuando un agroecosistema satisface demandas razonables de alimento sin imponer a la sociedad aumentos en los costos sociales de la producción. Para otros, la equidad se logra cuando la distribución de oportunidades o ingresos dentro de una comunidad mejora significativamente.
La estabilidad es la constancia de la producción bajo un grupo de condiciones ambientales, económicas y de manejo.
La productividad es la medida de la cantidad de producción por unidad de superficie, labor o insumo utilizado. El rendimiento por área puede ser un indicador de la producción y/o constancia de la producción, pero la productividad puede ser medida por unidad de labor o trabajo, por unidad de inversión de dinero, en relación con necesidades o en una forma de coeficientes energéticos.
2. AGROFORESTERÍA COMO ALTERNATIVA A LOS SISTEMAS AGROPECUARIOS CONVENCIONALES
La agroforestería involucra la aplicación de conceptos y principios ecológicos para el diseño y manejo de agroecosistemas sustentables. Existen variadas definiciones del concepto. Por su enfoque destacaremos las siguientes:
• Agroforestería es un grupo de prácticas y sistemas de producción, donde la siembra de los cultivos y árboles forestales se encuentran secuencialmente y en combinación con la aplicación de prácticas de conservación de suelo (Lanza et al. 1999);
• Agroforestería es el conjunto de técnicas de manejo de tierras que implica la combinación de árboles con cultivos o con animales, o la combinación de los tres. Tal combinación puede ser simultánea o secuencial, manteniendo el principio de rendimiento sustentable. En esta combinación debe haber una interacción significativa (Budowsky 1993).
Un caso especial de la Agroforestería son los sistemas agroforestales, en estos sistemas los árboles se destacan no sólo por su porte, sino también por sus aportes en términos de sombra, regulación de la temperatura, humedad, ciclaje de nutrientes, generando un microclima especial y mejoras al sitio forestal (Dorado 2018).
133 SISTEMAS AGROSILVOPASTORILES
Al respecto, merece la pena, revalidar los atributos que tornan sustentables estos sistemas, tal como se describió en párrafos previos. Un importante eslabón de posiciones controversiales en estos sistemas, son los planteos en esquemas denominados uso múltiple del bosque. Mientras para algunos están bastante alejados de los sistemas agroforestales puros para otros no. A saber:
Gregory (1980) define el uso múltiple como “el uso consciente y deliberado del terreno para la producción concurrente de más de un bien o servicio, que aplicado a los bosques resultaría en el uso consciente y deliberado de los bosques, considerando las múltiples funciones y productos que se pueden extraer del mismo”.
Mendez (2000), refiriéndose a las características principales del sistema agroforestal de producción de árboles en línea, mencionan que “cada línea de árboles asociados a cultivos-pastos representa en sí un sistema agroforestal, aunque también pueden formar parte de un esquema agroforestal compuesto por varias líneas dentro o alrededor de una finca o parcela”.
Lanza (1999) los clasifica como sistemas agroforestales secuenciales y simultáneos. En sistemas agroforestales sequenciales, existe una relación cronológica entre las cosechas anuales y los productos arbóreos; es decir, que los cultivos anuales y las plantaciones de árboles se suceden en el tiempo. Esta categoría incluye formas de agricultura migratoria con intervención o manejo de barbechos y métodos de establecimiento de plantaciones forestales en los cuales los cultivos anuales se llevan a cabo simultáneamente con las plantaciones de árboles, pero sólo temporalmente, hasta que el follaje de los árboles se encuentre desarrollado. Sistemas agroforestales simultáneos, consiste en la integración simultánea y continua de cultivos anuales o perennes, árboles maderables, frutales o de uso múltiple y/o ganadería. Estos sistemas incluyen asociaciones de árboles con cultivos anuales o perennes, huertos caseros mixtos y sistemas agrosilvopastoriles.
Dada la importancia y variedad de interpretaciones de ambos, presentaremos tópicos significativos de los mismos. En las regiones semiáridas y áridas de Argentina, los sistemas agroforestales y los planteos de uso múltiple del bosque revisten especial importancia no sólo por la productividad, el aporte de servicios ecosistémicos sino por su adaptabilidad y resiliencia, así como por la mejora sustancial en la provisión de agroalimentos y de calidad de vida de los pueblos involucrados. Estos sistemas proveen beneficios directos e indirectos. Sus aportes son cuantiosos, ya que en esas regiones, muchas de ellas marginales o en sus límites, resulta difícil instalar sistemas de producción como la agricultura y ganadería convencional. Estos sistemas, más complejos y sustentables, mejoran la rentabilidad de los sistemas y la calidad de vida de las poblaciones asociadas a los mismos. En este capítulo nos referiremos a ambos sistemas, ya sea para bosques cultivados como bosques nativos.
134 DESARROLLO SOSTENIBLE
3. USO MÚLTIPLE DEL BOSQUE
Algunos agroalimentos producidos en sistemas agroforestales y montes son:
3.1 Hongos
Los hongos se presentan como una rica fuente proteica y se pueden cosechar tanto en bosques nativos como cultivados. En el caso de la provincia de Córdoba, se los halla en el bosque serrano asociados a Fagara coco, especialmente en temporadas lluviosas, encontramos Boletus coco. Otros hongos del género Boletus que se encuentran en las serranías de Córdoba son Boletus suillus. La riqueza de estos hongos se aprecia en bosques cultivados con Pinus elliotti y Pinus taeda (Fig. 1).


Figura 1. A) Desarrollo de hongos comestibles (Boletus sp.) en el estrato inferior de un pinar (Pinus sp.) en zona serrana de Córdoba; B) secado artesanal de los hongos.
3.2 Arrope
Término de origen árabe: mosto cocido. También referenciado como dulce de (depende de cada fruta). En España, después de la vendimia, se hacía el arrope hirviendo mosto a fuego fuerte, éste se mezcla durante su cocción hasta alcanzar un punto de almíbar bien espeso (la cantidad que se puso a hervir se reduce a un tercio) (Camusso 2003).
En Argentina, Chile y Perú se denomina a todo dulce (muy dulce) elaborado con frutas que se hierven hasta quedar disueltas y endulzadas con el azúcar de sus propios jugos. Los más conocidos son el de tunas, mistol, chañar, pero también se hace con uvas y otras frutas (Camusso 2003).
El arrope es un dulce sin agregado de azúcar. En el Noroeste Argentino, es común el uso del arrope de mistol y de chañar con fines curativos y alimenticios (Fig. 2).
135 SISTEMAS AGROSILVOPASTORILES
A B


Figura 2. A) Frutos de Chañar (Geoffrea decorticans) en planta, previa cosecha; B) Frutos de Mistol (Zizyphus mistol) cosechados y envasados. Fotos: gentileza de Dr. R. Zapata.
Investigaciones realizadas por el “Consejo de Investigaciones de la Universidad Nacional de Tucumán (CIUNT) y de la Facultad de Bioquímica, Química y Farmacia validaron esos usos de manera experimental sometiendo las plantas a evaluaciones y pruebas de laboratorio. A través de dichas investigaciones, se verificaron cuatro propiedades de la fruta del chañar (efecto expectorante, antitusivo, antiinflamatorio y analgésico), y tres para su arrope (todas las anteriores menos la propiedad antiinflamatoria, que se perdería durante la cocción de la fruta) (Traslasierra 2017).
3.3 Miel y derivados
Es sabida la importancia de las mieles y la calidad de las mismas de acuerdo a los tipos de polen, así como la calidad del propóleo, jalea real, etc. En este caso, existe una relación de mutuo beneficio: las abejas obtienen su alimento y actúan como polinizadores. De allí, la importancia de incluir colmenas (Fig. 3) tanto para obtener agroalimentos naturales como para el uso sustentable de bosques.
Un apartado especial remite al propóleo, por su multiplicidad de usos. Ledesma (2017) menciona la composición de los mismos: 55% resinas, 25% cera, 10% aceites esenciales y volátiles, 5% polen, 5% sustancias minerales y orgánicas. Es rico en minerales y vitaminas A, B1, B2, B6, C, E y flavonoides. Usos: medicinal: antibiótico natural contra bacterias, hongos y virus, anestésico y antiinflamatorio, cicatrizante y regenerador de tejidos, antioxidante, estimulante del sistema inmunológico; alimenticio: caramelos de propóleos y miel con propóleos-en base a miel y extracto blando de propóleos, se utilizan para picazón y dolor de garganta.
136 DESARROLLO SOSTENIBLE A B


Figura 3. A) Colmenas en bosque de algarrobo (Prosopis sp.); B) Extracción de miel. Fotos: gentileza de Dr. R. Zapata.
3.4 Gomas y exudados
La brea (Parkinsonia aculeata) es conocida como una especie de cicatrización presente en los bosques de la región chaqueña, en especial en ecosistemas perturbados. No sólo es valiosa por su rol y servicios ecosistémicos, sino también porque exuda naturalmente una goma dulce que la gente conoce como caramelitos del monte (Fig. 4).



Figura 4. Exudados de algarrobo y brea. A) Algarrobo (Prosopis sp.), B) exudado natural de Brea (Parkinsonia aculeata) y C) exudado provocado para su cosecha. Fotos: gentileza de Dr. R. Zapata.
La brea tiene multiplicidad de usos. Los mismos han sido descriptos por investigadores de INTA como, uso alimentario: caramelito del monte; aditivo natural aceptado por el Código Alimentario Argentino en 2013, de uso en confitería: da brillo, demora la cristalización del azúcar, da consistencia
137 SISTEMAS AGROSILVOPASTORILES
A B
A B C
a mermeladas, jarabes, caramelos y coberturas comestibles, panificación: conserva mejor la humedad e integridad del pan, heladería: reduce el tamaño de los cristales de hielo, cervecería: estabiliza las espumas, fijando las burbujas del gas carbónico, alimentos balanceados: permite aglutinar los componentes de las mezclas, medicinal: los pobladores rurales usan los pedacitos de goma como suavizante de la garganta y para disminución de la tos, cueros: humectante y suavizante, cosmético: humectante, suavizante y emulsionante de la piel, farmacéutico: aglutinante y estabilizante en preparados sólidos y líquidos, textil y gráfica: da apresto a las telas y facilita la impresión offset, pinturería: aglutinante para preparar temperas y acuarelas, artes plásticas: adhesivo para papel y cartón y barniz protector, alfarería: para restauraciones, como adhesivo, fijador y barniz, construcción en barro: como adhesivo, fijador y barniz protector.
3.5 Sustancias tintóreas y/o de uso en farmacopea Chañar (Geoffrea decorticans) se puede considerar un árbol multiproposito valioso, siendo una especie tintórea, alimenticia y de uso medicinal (Coirini 2015)(Fig. 5).

Figura 5. Corteza de Chañar (Geoffrea decorticans) de la que se extraen sustancias tintóreas. Fotos: gentileza de Dr R. Zapata.
3.6 Otros usos alimenticios de frutos del bosque, para alimentación humana Debido a su uso y al valioso aporte nutricional (Fig. 6), en el 2014, la harina y la vaina de algarrobo, así como el patay fueron incorporadas al Código Alimentario Argentino (2019). Este los incluye de la siguiente manera: • “Art. 681: Con el nombre de harina de algarroba, se entiende el producto de la molienda de las semillas, limpias, sanas y secas, del algarrobo blanco (Prosopis alba Griseb) y/o algarrobo negro (Prosopis nigra (Grisebach) Hieronymus)”;
138 DESARROLLO SOSTENIBLE
• “Art. 758: Con el nombre de Patay, se entiende el producto elaborado por amasado de harina de algarrobo, cualquiera de sus tipos: semilla o fruto, con agua; masa a la que se le da forma de panes antes de llevarla al horno para cocerla. La pasta análoga con harina de Mistol (Zyziphus mistol) se denomina: Patay mistol”
En relación a la harina de algarrobo, Martinez (2018) refiere que: “por molienda y tamizado de las algarrobas secas se obtiene la harina de algarroba. Es un alimento altamente energético, con 230 kcal/100 g, dado por su alto contenido (39-46 %) de azúcares naturales simples y solubles (fructosa, glucosa y sacarosa). Es muy rica en proteínas (8-19 %) de alto valor biológico, por la presencia de aminoácidos esenciales. Es notable su riqueza en minerales indispensables: hierro, calcio, magnesio, manganeso, zinc, cobre y fósforo, destacándose su alto contenido en potasio. Es muy rica en vitaminas A, B1, B2 y D indispensables y vitamina E que es un antioxidante que ayuda a reducir el colesterol y prevenir enfermedades cardiovasculares y del sistema nervioso. No posee gluten, por lo cual es apta para celíacos”.

Figura 6. Productos alimenticios elaborados con frutos de algarrobo. Foto: gentileza de Dr. R. Zapata.
3.7 Trojas de chauchas de algarrobo como suplemento forrajero El aporte forrajero de los Prosopis es importante, no sólo porque provee materia seca en el período de bache forrajero, sino también “por la calidad que posee (alto porcentaje de proteínas, especialmente en las hojas, con 15% a 25% de proteína bruta) y por la energía que aporta (alto porcentaje de hidratos de carbono, especialmente en frutos: 50% a 70% de hidratos de carbono). Los frutos son preferidos sobre el follaje (Polini 2018)”.
139 SISTEMAS AGROSILVOPASTORILES
4. SISTEMAS AGROFORESTALES
En los sistemas agroforestales el rol protagónico recae en los planteos agrícolas asociados al bosque. Al respecto, Norfol (2008) mencionan entre sus ventajas: valorización del recurso forestal, maximiza y estabiliza la producción total del sistema biológico; produce y ofrece más de un producto; neutraliza el efecto de ciertas oscilaciones económicas por poder ofrecer más de un producto para ser comercializado y por poder elegir insumos accesibles según el sistema productivo seleccionado. Por su parte, Salazar (2015) referencia que “en algunas áreas o localidades, el uso de Prosopis spp. ya es una realidad, pero todavía falta mucho camino además del forraje y sombreado, como alimentación humana y fabricación de subproductos, usos medicinales, cortinas rompevientos, entre otras tantas funciones. El mejoramiento e implementación de sistemas agroforestales es necesario para superar la crisis económica y alimenticia que se ha visto los últimos tiempos.” Los sistemas agroforestales han mostrado mejores rendimientos en condiciones bajo riego. Al respecto, Plevich (2015) realizó estudios en zona SO de Córdoba comparando monocultivo de trigo y su inclusión mismo en sistemas agroforestales (integrados por álamo y trigo) en condiciones de cultivo a secano y bajo riego. Los resultados del estudio mostraron un rendimiento de granos menor en el sistema agroforestal en secano, superado por el cultivo monoespecífico en secano, pero este produjo menos que el sistema agroforestal y el cultivo puro regados, que no difirieron entre sí. En el sistema agroforestal los árboles respondieron significativamente al tratamiento de riego logrando mayor producción de madera que la condición de secano. Se puede concluir que la mayor productividad de cada estrato se logró en el sistema agroforestal con riego.
Por su parte, Galera (2000) realizó estudios en zona de Quilino (Córdoba) en sistemas agroforestales con Prosopis plantado en damero, distanciados entre sí y entre líneas de cultivo 4 m intercalando cultivos de poroto alubia y maíz Flint 360. Ellos obtuvieron rendimientos de 33 quintales/hectárea para maíz cultivado bajo la copa del árbol y área de influencia. Esto se atribuyó a la biofertilización (aporte de nitrógeno por el Prosopis). Lo expresado evidencia la importancia de los árboles en los sistemas agroforestales, brindando variedad de productos y servicios, agregando valor y mejorando las economías y la calidad de vida de los lugareños.
5. SISTEMAS SILVOPASTORILES
Dentro de los agroecosistemas se encuentran los sistemas silvopastoriles que como su denominación lo indica, son aquellos en los que interviene el componente animal que interactúa con leñosas de aptitud forestal que crecen en asociación con hierbas de valor forrajero y animales, en un arreglo espacial
140 DESARROLLO SOSTENIBLE
y temporal, con múltiples interacciones ecológicas y económicas conformando sistemas complejos y diversos (Arias 2014).
El aumentar la biodiversidad y la biomasa favorece la sustentabilidad de la producción diversificando las actividades logrando un aprovechamiento mixto y complementario de todos los componentes del sistema.
Entre los tipos de sistemas silvopastoriles, debido a las múltiples combinaciones factibles, podemos mencionar:
• Pastoreo en bosques naturales;
• Pastoreo en plantaciones forestales para madera;
• Pastoreo en huertos;
• Pastoreo en plantaciones de árboles con fines industriales;
• Praderas con árboles o arbustos forrajeros o multipropósito para corte;
• Sistemas agroforestales especializados para la producción animal intensiva.
El estrato arbóreo alto en estos sistemas proporciona una media sombra que favorece la creación de un microclima en el cual se mantienen los forrajes de calidad por períodos más prolongados. El reduce la velocidad del viento, da cobertura en el período frío y provee de sombra al ganado en la época de alta radiación solar, disminuye las diferencias térmicas día-noche favoreciendo el confort del animal a campo lo que repercute en una mejor eficiencia de producción. También ayudan con la extracción de nutrientes del subsuelo aumentando la producción de pasturas. Proporcionan tanto frutos como follaje caducifolio que los animales pueden aprovechar en ciertas épocas del año, referenciadas como bache forrajero (cuando las pasturas escasean).
Este estrato es muy importante para la estabilidad del sistema en tanto el estrato arbustivo, compuesto de árboles de menor porte y arbustos para ramoneo. Es otro componente forrajero que junto con el estrato herbáceo constituyen la base de alimentación de los animales. La presencia de variados tipos y calidades de forraje permite a los animales variar su dieta y de esta manera poder balancearla mejor de acuerdo a sus requerimientos, potencial y época del año.
El aprovechar la producción en follaje y frutos de estratos múltiples de plantas destinadas específicamente a alimento para los animales, representa uno de las mayores oportunidades para intensificar la producción pecuaria de manera sustentable disminuyendo la dependencia de recursos alimentarios externos. Además diversifica la producción y permite la interacción entre los distintos componentes del sistema proporcionando sustentabilidad.
Algunos de los beneficios de incorporar animales que podemos mencionar son los siguientes:
• La presencia de ganadería en la explotación obliga a incluir los pastos, forrajes y otros cultivos para la alimentación animal en las rotaciones que en general contribuyen de manera importante a mantener e incluso aumentar la fertilidad del suelo;
141 SISTEMAS AGROSILVOPASTORILES
• Existen zonas cuyo aprovechamiento agrícola sólo es posible mediante la producción animal. En éstas es la agricultura la que viene a complementar a la ganadería y no al revés. En muchas zonas amenazadas por la deforestación, la implantación de sistemas de producción animal permite una lucha eficaz contra este problema;
• Permiten aprovechar ventajosamente pasturas, forrajes y subproductos agrícolas ofreciendo alimentos de gran valor nutricional;
• El estiércol, materia orgánica rica en nitrógeno y microorganismos, es importante para una adecuada dinámica en el proceso de humificación de la materia orgánica, necesario para lograr un adecuado equilibrio en los caracteres físicos, químicos y biológicos del suelo. El aporte significativo de materia orgánica al suelo a través de las deyecciones mejora la fertilidad y contribuye al logro de un mayor equilibrio y estabilidad de los sistemas;
• Estos sistemas constituyen una buena alternativa para conservar y promocionar razas autóctonas (Arias 2014);
• Los productos alimenticios de origen animal contribuyen a lograr un equilibrio de la dieta humana a la que proporcionan una gran calidad organoléptica y nutritiva;
• El ganado mantiene el suelo libre de malezas, facilita el acceso a la forestación y evita la aplicación de herbicidas;
• También se incluyen animales para control de incendios (Fig. 7) ya que los mismos consumen el estrato herbáceo disminuyendo las posibilidades de que ocurran incendios con el beneficio de convertir el pastizal seco en productos de alta calidad;
• Permite retornos económicos más rápidos que los de la forestación;
• Diversifica la producción de la empresa, reduciendo los factores de riesgo biológicos y de mercado.

Figura 7. Cabras ramoneando a la salida del invierno (época del bache forrajero), en zona de monte serrano de la Provincia de Córdoba, Argentina.
142 DESARROLLO SOSTENIBLE
Teniendo en cuenta todo lo anterior podemos decir que un sistema silvopastoril es aquel uso de la tierra donde las leñosas de aptitud forestal crecen en asociación con hierbas de valor forrajero y animales (domésticos y/o silvestres), en un arreglo espacial y temporal, con múltiples interacciones ecológicas y económicas entre los componentes del sistema. En otras palabras, un sistema silvopastoril es el que permite que los componentes citados (árboles forestales, pasturas y animales de producción), se ubiquen bajo un esquema de manejo racional integral, que tienda a mejorar a mediano o largo plazo, la productividad, la sustentabilidad y la rentabilidad de la explotación; teniendo en cuenta, las diferentes condiciones y tiempos de producción (Arias 2015).
Lo enunciado, implica que el manejo de este tipo de sistemas involucra el conocimiento y la interacción de las numerosas variables que afectan a cada uno de los componentes, sin olvidar los recursos suelo y agua. Se producen así una serie de interacciones que condicionan la productividad de cada componente y del conjunto.
5.1 Aporte de las cabras y ovejas a los sistemas silvopastoriles
Es importante el aporte de los sistemas ovinos y caprinos a la sustentabilidad concebida como un sistema económico, social y ecológico. La gran capacidad de adaptación y el comportamiento alimentario permite que aprovechen mejor que otras especies, los ambientes limitantes y se adapten con éxito a sistemas silvopastoriles (Arias et al. 2013).
Desde un punto de vista estratégico, no ocupan un nicho ecológico que compita con el hombre, por cuanto estas especies utilizan para producir recursos de escaso valor. La dieta anual está formada mayormente por matorrales, malas hierbas (arvensis), especies arbustivas y arbóreas, hojas y frutos (Fig. 7). Estas especies, poseen una gran potencialidad para el desarrollo de sistemas altamente tecnificados o como una alternativa importante para la diversificación de la producción; debido a la calidad y diversidad de productos que brindan al hombre. Poseen además una gran capacidad de adaptación a distintos ambientes y sistemas productivos, lo que las hacen aptas para integrarlas a otros sistemas de producción, como ser: cultivos agrícolas extensivos, producción de bovinos, agrícolas intensivos, frutícolas, maderables y otros con los que puede desarrollarse ampliamente; utilizando para su alimentación residuos o subproductos de esos sistemas de producción, logrando de esta forma la diversificación e integración.
Otros aspectos que repercuten favorablemente para la difusión de estas especies son el bajo costo de su producción, la obtención de ganancias rápidas, la facilidad para su alimentación y la diversidad de productos que ellas mismas brindan entre los que podemos mencionar carne, leche y sus derivados, fibra (mohair y cachemira), piel y lana.
143 SISTEMAS AGROSILVOPASTORILES
5.2
Sistemas silvopastoriles bovinos
Al citar la sostenibilidad ecológica de los procesos, se hace primordial referencia, al mantenimiento de la producción a lo largo del tiempo realizando explotaciones siempre por debajo de los límites de renovación que pueden tener estos sistemas naturales. Se debe considerar el producir garantizando la disponibilidad de recursos a las generaciones futuras, sin pensar que la oferta de recursos es ilimitada en cantidad y disponibilidad.
El avance de la producción agrícola en la República Argentina desplazó a la ganadería a zonas marginales, generando un incremento en la presión animal, sobre sistemas agroecológicos frágiles, superando su resiliencia.
Este nuevo escenario de producción genera la necesidad de optimizar los recursos disponibles, para obtener sistemas estables, sin perder de vista el concepto de sostenibilidad. Para ello es imprescindible adaptar la producción a los ecosistemas y no viceversa. Concentrando el enfoque en cómo mejorar la oferta forrajera generando el menor impacto posible, en especial para la producción de ganado bovino.
Al considerar los sistemas naturales como fuente de alimentación para la producción ganadera, es fundamental plantearse como objetivo alcanzar el equilibrio entre la estabilidad del sistema natural y la producción que este puede brindar. La producción ganadera óptima, es aquella que se realiza en función de la capacidad de producción de materia seca y la calidad nutricional de las especies presentes en el sistema natural, las cuales son empleadas para el aporte de nutrientes de los bovinos, evitando la pérdida de biodiversidad por presión de consumo.
La comprensión de estos sistemas, sus variaciones temporales, su estructura espacial, la oferta vegetal, junto a la dinámica del proceso de pastoreo es clave para optimizar la producción del ganado sin deteriorar los sistemas. Con los fines de planificar la producción de ganado bovino, se debe proceder a realizar un inventario de la composición florística del pastizal natural, así como una clasificación de las especies con la que se cuenta. Para ello se pueden utilizar distintos criterios:
Criterio ecológico: considera la dinámica poblacional a lo largo del tiempo se pueden, clasificar a las especies como a) decrecientes: aquellas que por palatabilidad y elección de los animales sufran mayor presión de pastoreo, b) crecientes: las que crecen en función de la disminución de las especies decrecientes, c) invasoras: especies de baja palatabilidad y mejor adaptación los espacios degradados, con estrategias de adaptación que les permiten colonizar e invadir los espacio.
Criterio de uso: de acuerdo a la utilidad de ciertas especies potencialmente forrajeras en la producción de carne bovina, se clasifican en a) especies preferidas, b) intermedias e c) indeseables. Siendo las preferidas las que presentan una dinámica decreciente, las intermedias una actividad creciente, y las invasoras.
144 DESARROLLO SOSTENIBLE
El conocimiento de las especies presentes en el monte natural y su dinámica de crecimiento junto a la palatabilidad permite definir tanto la carga animal instantánea, como el tipo de manejo que debe realizarse en cada ambiente para evitar su degradación.
Dada la variedad de sistemas en la producción forrajera de los sistemas naturales se obtienen distintos rendimientos. Si puede definirse en función de los kilogramos de materia seca que pueden ser obtenidos de dichos sistemas, así en zonas áridas es de esperar la obtención de entre 500 a 1700 Kg de materia seca siendo equivalente a 5 Kg de carne por ha. En zonas semiáridas debido a la mayor oferta hídrica las producciones de forrajes varían entre 1000 y 2500 Kg de materia seca, que traducidos a kilos de carne se acercan a los 20 Kg por ha.
Al estudiar los sistemas naturales de zonas subhúmedas se observa un incremento en la producción de materia seca que puede alcanzar los 4000 Kg, si el estado de conservación es bueno, esto permite la obtención de un promedio de 50 Kg de carnes por ha.
Existen algunos indicadores que permiten la evaluación del estado del pastizal natural, Los indicadores utilizados pueden ser la presencia de las especies predominantes (sean preferidas, intermedias o invasoras), el vigor de las mejores especies que presentan en el ambiente, el porcentaje de suelo desnudo, la producción de kilos de materia seca, o la receptividad definida por hectáreas por unidad ganadera.
En la utilización de monte silvestre, es fundamental la planificación de un sistema rotativo de pastoreo con tiempos de descansos que permitan la floración, fructificación y semillado, sobre todo de aquellas especies que tienen una alta presión de consumo por parte de los animales presentes en el lote.
C ONSIDE r ACIONES FINALES
Frente a los nuevos escenarios mundiales donde es fundamental la conservación de la biodiversidad, pero sin dejar de alimentar una población mundial (en exponencial crecimiento), es primordial el planteo de nuevos paradigmas productivos, que apunten a la sostenibilidad de los planteos agroalimentarios, realizando los menores impactos ambientales posibles en el proceso de producción de alimentos.
Los sistemas silvopastoriles bovinos se han dado a conocer por desarrollarse mediante el uso de tecnologías que involucran el progreso de los sistemas ganaderos al mismo tiempo que proporcionan beneficios ambientales por medio de técnicas que se emplean en las diferentes actividades agrícolas en las que se aprecian los árboles y los arbustos como componentes esenciales para la industria animal, teniendo en cuenta que estos ayudan a aumentar la calidad y el rendimiento de los pastos, contribuyen con la reducción de
145 SISTEMAS AGROSILVOPASTORILES
la emanación de gases efecto invernadero que se relaciona directamente con el cambio climático. Ayuda a diversificar la producción, mejorando su rentabilidad mediante el uso racional de los recursos naturales, al propiciar una producción sustentable a nivel técnico, productivo y económico. Favorece a la conservación de la biodiversidad, al amparar las cuencas hídricas y enriquecer las propiedades biológicas y fisicoquímicas del suelo.
En relación a los sistemas silvopastoriles intensivos podemos decir que durante la mayor parte del año se mantiene la producción de forraje, la carga ganadera, el peso y condición corporal de las vacas, así como la producción constante de leche y carne. Esto permite mejorar ingresos de la unidad productiva, debido al bajo costo que supone la alimentación del ganado, la cual depende básicamente del forraje que se produce en la superficie disponible.
REFERENCIAS BIBLIOGRÁFICAS
Alonso J (2011) Los sistemas silvopastoriles y su contribución al medio ambiente. Revista Cubana de Ciencia Agrícola, 45(2):107-115.
Altieri M y Nicholls C (2012) Agroecología: Única esperanza para la soberanía alimentaria y la resiliencia socioecológica. Una contribución a las discusiones de Rio+20 sobre temas en la interface del hambre, la agricultura, y la justicia ambiental y social. 21p.
Altieri M (1988) Environmentally Sound Small Scale Agricultural Projects. Universidad de California, Berkeley, 176p.
Andrade F (2017) Los desafíos de la agricultura Argentina. https://inta.gob.ar/ sites/default/files/lib_desafiosagricultura_2017_online_b.pdf. Acceso Abril 2019.
Arciniegas-Torres SP, Flórez-Delgado DF (2018) Estudio de los sistemas silvopastoriles como alternativa para el manejo sostenible de la ganadería. Ciencia y Agricultura, 15(2):107-116.
Arias M (2014) Efecto de la suplementación estratégica sobre parámetros reproductivos y productivos en dos estaciones de parición en cabras regionales. Tesis Doctoral. Universidad Católica de Córdoba y Biblioteca Facultad De Ciencias Agropecuarias.
Arias M (2015) Influencia de la suplementación estratégica sobre el peso al nacimiento de cabritos en dos estaciones de parición en sistemas silvopastoriles. 3°Congreso Nacional de Sistemas Silvopastoriles. VII Congreso Internacional Sistemas Agroforestales. Misiones, Argentina
Arias M, Alonso A, Molina, MG (2013) Aumento de la condición corporal en caprinos por efecto de la suplementación estratégica en un sistema silvopastoril en Córdoba Argentina. XXIII reunión ALPA y FOCAL, la Habana Cuba.pp.23-24.
Budowski G (1993) Agroforestería: Una Disciplina Basada en el Conocimiento Tradicional. Revista Forestal Centroamericana. CATIE, Turrialba, Costa Rica. 2(3):14-18.
146 DESARROLLO SOSTENIBLE
Camusso C, Dorado M (2003) Notas del proyecto Arrope total. Sistemas agrosilvopastoriles Córdoba, Argentina FCA-UNC. 8p. Código Alimentario Argentino (2019) Ley 18284 y sus actualizaciones. Resolución conjunta 222/2013 y 331/2013.
Coirini R, Zapata R, Contreras A (2015) Técnicas y herramientas de corte y cosecha para la producción de goma de brea (Cercidium praecox). MAMFacultad de Ciencias Agropecuarias. Universidad Nacional de Córdoba, Argentina.
Dorado M (2018) Notas de curso: Módulo Forestería y Agroforestería. Área Gestión Ambiental y Producción Sostenible, FCA-UNC. Córdoba, Argentina, 21p.
Estrada López I et al. (2018) Evaluación productiva y económica de un sistema silvopastoril intensivo en bovinos doble propósito en Michoacán, México. CIENCIA ergo-sum, 25(3):1-13. doi.org/10.30878/ces.v25n3a7.
FAO (2001) Proyecto Información y análisis para el manejo forestal sostenible: integrando esfuerzos nacionales e internacionales en 13 paises tropicales en América Latina. http://www.fao.org/tempref/GI/Reserved/FTP_FaoRlc/ old/proyecto/rla133ec/Informes%20Regionales-pdf/Pfnm.pdf Acceso Abril 2019.
Galera F (2000) Las especies del género Prosopis (Algarrobos) de América Latina con especial énfasis en aquellas de interés económico. Talleres Gráficos Graziani Gráfica. http//www.fao.org/3/AD314S/AD314S00.html. Acceso Abril 2019.
García Martínez A (2018) Evaluación productiva y económica de un sistema silvopastoril intensivo en bovinos doble propósito en Michoacán, México. CIENCIA ergo-sum, 25(3):1-14.
Gliessman S (1998) Agroecology: ecological process in sustainable agriculture. Chelsea USA: Ann Arbor Press, 653p.
Salazar G (2015) Uso del género Prosopis en Sistemas Agroforestales y Silvopastoriles de algunos países Latinoamericanos. https://www. academia.edu/29273644/Uso_del_Algarrobo_Prosopis_spp_en_Sistemas_ Agroforestales_y_Silvopastoriles_de_Pa%C3%ADses_Latinoamericanos, Acceso Octobre 2019.
INTA (2013). Sistemas silvopastoriles. http://inta.gob.ar/documentos/ sistemas-silvopastoriles. Acceso Marzo 2019.
INTA (2017) Herramientas para contribuir al manejo y el uso múltiple sustentable del bosque nativo. https://inta.gob.ar/proyectos/PNFOR-1104082.
Karlin M, Ulf K., Coirini R, Reati G, Zapata, R (2013) El libro del Chaco Arido. http://redaf.org.ar/libro-el-chaco-arido/ Acceso Marzo 2019.
Kaspar G y Galletti M (2019) Sistemas agroforestales. EEA INTA Balcarce. https://inta.gob.ar/noticias/sistemas-agroforestales. Acceso Marzo 2019. Krishnamurty L y Marcelino A (1999) Agroforestería básica. PNUMA, 339p.
Lanza G, Minnick G, Villegas V, Irahola J, Gastón C (1999) Educación ambiental para el trópico de Cochabamba. Proyecto “Jatun Sach’a”. http://www.fao. org/3/ah647s/AH647S04.htm. Acceso Marzo 2019.
Ledesma M et al. (2019) Cartilla de Brea. https://inta.gob.ar/sites/default/ files/inta_goma_brea.pdf. Acceso Abril 2019.
147 SISTEMAS AGROSILVOPASTORILES
Ledesma M (2019) Cartilla Propóleos. https://inta.gob.ar/sites/default/files/ inta_propoleos.pdf. Acceso Marzo 2019.
Martinez J, Ledesma M (2019) Cartilla de Algarroba. https://inta.gob.ar/sites/ default/files/inta_cartilla_algarroba.pdf. Acceso Marzo 2019.
Mendez E, Beer J, Faustino J, Otárola A (2000) Colección módulos de enseñanza agroforestal Módulo 1. CATIE, Turrialba. Costa Rica, 134p.
Plevich O et al. (2015) Producción de grano y madera en un sistema agroforestal usado como filtro verde. En actas VIII Congreso internacional sistemas agroforestales para la producción pecuaria y forestal sostenible, pp.12-18.
Polini G (2018) El Algarrobo: El arbol divino de los indigenas del Chaco, Comer del Monte, 4, 34p.
Rearte D (2007) Distribución territorial de la ganadería vacuna. Programa Nacional de Carnes. Instituto Nacional de Tecnología Agropecuaria. Buenos Aires Argentina. 26p.
Ríos N, Cejas M, Maldonado M (2008) Sistemas productivos en el Chaco Semiárido, Argentina. http://fcf.unse.edu.ar/archivos/quebracho/ne-a04. pdf. Acceso Marzo 2019.
Sarandón S, Flores C (2014) Agroecología: bases teóricas para el diseño y manejo de Agroecosistemas sustentables. Universidad Nacional de La Plata. http://sedici.unlp.edu.ar/handle/10915/37280. Acceso Marzo 2019.
Silva-Pando F, Rozados Lorenzo MJ (2002) Agroselvicultura, Agroforestería, prácticas agroforestales, uso múltiple: una definición y un concepto. En: Cuad. Soc. Esp. de Cien. Fores. 4(2002). “Actas de la primera reunión de ciencias forestales- I reunión de espacios naturales”, pp.9-21.
148 DESARROLLO SOSTENIBLE
ESTRATEGIAS PARA UNA PRODUCCIÓN SUSTENTABLE EN GANADErÍA
María Verónica Aimar
Universidad Nacional de Córdoba (UNC), Facultad de Ciencias Agropecuarias, Cátedra de Producción de Leche, Félix Aldo Marrone 746, Ciudad Universitaria, (5000) Córdoba, Argentina, E-mail: veraimar@agro.unc.edu.ar
INTRODUCCIÓN
La demanda actual de productos alimenticios se caracteriza no sólo por una creciente sensibilidad de la población respecto a su calidad higiénicosanitaria y nutricional en relación con la salud, sino también a una preocupación por la forma en que han sido producidos. Como es ampliamente conocido, existe una necesidad de mejorar la productividad, la eficiencia y rentabilidad de los sistemas agropecuarios, el desafío es hacerlo de una manera sustentable. Según estimaciones de la Organización de las Naciones Unidas para la Agricultura y la Alimentación (FAO 2017a), en el 2050, para abastecer la demanda mundial de la población, la agricultura tendrá que producir casi 50% más de alimentos que en 2013. Si bien los avances tecnológicos permiten un uso más eficiente de los recursos y una mayor producción de alimentos, esto último, podría peligrar debido a una mayor presión sobre los recursos naturales y al cambio climático.
En ese contexto, los sistemas ganaderos también deben ser más productivos y eficientes en vista a las necesidades futuras, enfrentando las problemáticas relacionadas al agotamiento de los recursos naturales y al cambio climático. Ahora bien, ese aumento de la productividad de los sistemas ganaderos podría generar impactos ambientales significativos (FAO 2006), amenazando la sustentabilidad de los sistemas.
Una de las maneras de ayudar a reducir sustancialmente las emisiones de gases de la producción ganadera y trabajar en pos de la sustentabilidad, es a través de la mejora de la productividad y de la implementación de buenas prácticas. La FAO (2017b) estima que mejorando las prácticas de cría se pueden reducir las emisiones de gases entre un 20 y un 30% en todos los sistemas de producción, y que las prácticas de conservación de recursos como la agricultura de conservación y la Agricultura Climáticamente Inteligente (CSA) proporcionan nuevos métodos para incrementar la productividad de manera sostenible. Se considera de importancia profundizar en la CSA para entender cómo trabajar en pos de la misma. La definición más comúnmente utilizada la proporciona la
149
9 Stadnik
MJ, Velho AC, Zorrilla SE (eds.) Desarrollo Sostenible en la Producción Agroalimentaria
FAO (2010) que define a la CSA como “un enfoque que ayuda a orientar las acciones necesarias para transformar y reorientar los sistemas agrícolas a fin de apoyar de forma eficaz el desarrollo y garantizar la seguridad alimentaria en el contexto de un clima cambiante”, o también como, “agricultura que aumenta de forma sostenible la productividad”. El aumento de la productividad es consecuencia de una mayor eficiencia en el uso de los recursos. Los tres pilares de CSA son: 1) aumentar la productividad, la seguridad alimentaria y el desarrollo; 2) aumentar la capacidad de adaptación en múltiples niveles y 3) disminuir las emisiones de gases con efecto de invernadero (GEI) y aumentar los sumideros de carbono C3 (Campbell et al. 2014, Lipper et al. 2014). Gerber et al. (2013) plantean que existe un fuerte vínculo entre la intensidad de las emisiones y la eficiencia del uso de los recursos, afirmando que la mayoría de las intervenciones de mitigación se traducirán en una mayor eficiencia en el uso de los mismos. Las posibles intervenciones para reducir las emisiones se basan, en gran medida, en tecnologías y prácticas que mejoran la eficiencia de la producción individual del animal y también del rodeo o hato. Si bien las intervenciones de mitigación obviamente deben adaptarse a los objetivos y condiciones locales, recomienda algunas ampliamente definidas para rumiantes:
• A nivel animal: optimizar la digestibilidad del alimento y el balance de las dietas, mejorar la salud animal y el rendimiento en la crianza;
•
A nivel de hato o rodeo: reducir la proporción de animales improductivos. Esto se puede lograr mejorando la alimentación, la salud y la genética, pero también a través de prácticas de manejo destinadas a reducir la edad al primer parto, ajustar los pesos, edades de sacrificio y tasas de reemplazo;
• A nivel de unidad de producción: en sistemas de pastoreo, mejorar el manejo de pasturas, pastizales para aumentar la calidad del alimento y la retención de carbono, y mejorar la gestión de estiércol entre otras;
• A nivel de la cadena de suministro: aumentar la provisión de carne suministrada por hatos o rodeos que producen carne y leche, adoptar prácticas y equipos de eficiencia energética y fomentar la minimización de residuos a lo largo de todas las cadenas de suministro.
Finalmente, Gerber et al. (2013) expresa que “la producción de carne y leche tiene mayor intensidad de emisión en sistemas caracterizados por baja productividad, debido a la baja digestibilidad del alimento, prácticas de manejo menos eficientes y al bajo rendimiento reproductivo”.
Investigadores del Centro Agronómico Tropical de Investigación y Enseñanza de Costa Rica (CATIE), reportan antecedentes de trabajos de implementación de sistemas silvopastoriles unidos a una serie de buenas prácticas de manejo ganadero con resultados exitosos para el mejoramiento de la productividad y la rentabilidad, la generación de servicios ecosistémicos, la re-
150 DESARROLLO SOSTENIBLE
ducción de la huella de carbono y la adaptación al cambio climático frente a la ganadería basada en enfoques tradicionales (Moreira y Castro 2016). También, en el marco de la Plataforma para la Intensificación Sostenible de la Ganadería, muestran resultados relevantes sobre buenas prácticas y su relación con la promoción de la intensificación de la ganadería sostenible y la reducción de emisiones de gases con efecto de invernadero (Casasola 2019).
Por lo tanto, las Buenas Prácticas (BP) son una herramienta clave para trabajar en pos de la sustentabilidad y de la CSA, ya que tienden a disminuir las externalidades negativas. Además, en la actualidad, las BP son un componente de competitividad, con impactos positivos tanto para la agricultura como la ganadería y el resto de los sectores productivos. Una metodología sistemática de trabajo, basándose en las BP, dará una visión objetiva a partir de la cual se obtendrán fundamentos sólidos para la toma de decisiones en la estrategia de mejora de sistemas climáticamente inteligentes y sustentables.
Por lo expuesto, el objetivo de este capítulo es presentar alternativas y herramientas disponibles de BP como una estrategia para trabajar en pos de la sustentabilidad. Ahora bien, es importante definir qué son las Buenas Prácticas Agrícolas (BPA) o específicamente para las producciones ganaderas, las Buenas Prácticas Pecuarias (BPP) y los objetivos que persiguen.
1. B UENAS P RÁCTICAS A GRÍCOLAS (BPA) y P ECUARIAS (BPP)
Según el concepto de la FAO (2006), las BP se pueden definir como “Aplicación del conocimiento disponible para la utilización sostenible de los recursos naturales básicos en la obtención de productos agro-alimentarios y no alimentarios, inocuos y saludables, a la vez que procuran la viabilidad económica y la estabilidad social”. Una definición más sencilla (FAO 2006) es “Hacer las cosas bien y dar garantías de ello”. En la Figura 1 se presentan los cuatro objetivos que persiguen las BPP: lograr la inocuidad de los alimentos, la seguridad de las personas, el bienestar animal (BA) y el cuidado del ambiente (el social y el medioambiente).
Los sistemas ganaderos son complejos, con una serie de variables que deben interactuar perfectamente para obtener un resultado óptimo. Toda herramienta que permita mantener esas variables bajo control será fundamental para lograr la calidad de producto deseado en sistemas sustentables y CSA. Las BP son una de ellas y según lo que sugiere diversa bibliografía (Sarandon 2002, Tomassino et al. 2012), la definición y evaluación de indicadores también son necesarios para conocer y mejorar los sistemas. Según Sarandon (2002), el uso de indicadores, ayudará a comprender, sin ambigüedades, los puntos críticos de la sustentabilidad de un agroecosistema. Esto permitirá realizar un diagnóstico de todo el proceso productivo, con una visión sistemática que permitirá detectar puntos críticos que afectan la productividad y sustentabilidad.
151 PRODUCCIÓN SUSTENTABLE EN GANADERÍA

Figura 1. Áreas u objetivos relativos a las Buenas Prácticas Pecuarias (BPP).
La implementación de BP, junto a la medición de indicadores posibilitará generar metodologías sistematizadas para la gestión y/o evaluación de los sistemas ganaderos, que darán una visión objetiva a partir de la cual, se obtendrán fundamentos sólidos para la toma de decisiones en la estrategia de la mejora de la sustentabilidad de los sistemas.
Existen numerosas herramientas para trabajar en pos de las BP, en este sentido es importante conocer algunas de las disponibles on line. Los protocolos de origen europeo para la calidad y el bienestar animal como GLOBALG.A.P, Welfare Quality® y los elaborados por FAO son referentes internacionales, utilizados como benchmarking por muchos países. En Europa, el Proyecto Welfare Quality® (2013), se originó para desarrollar normas europeas de evaluación de las explotaciones ganaderas (ganado bovino, ovino y aves de corral) y estrategias prácticas para mejorar el bienestar de los animales. Los parámetros principales en los que se basa son indicadores animales, y en el caso de que no existan o no sean confiables, se utilizan indicadores basados en los recursos o en las prácticas de manejo. Los protocolos GLOBALG.A.P (2018) tuvieron su origen en 1997 como EUREPGAP, una iniciativa del sector minorista agrupado bajo EUREP (EuroRetailer Produce Working Group) buscó armonizar sus normas, procedimientos y desarrollar un sistema de certificación independiente para las Buenas Prácticas Agrícolas. Están disponibles en varios idiomas y para diferentes
152 DESARROLLO SOSTENIBLE
tipos de producciones (cultivos a granel, flores y ornamentales, frutas y hortalizas, ganado bovino, ovino, aves, peces y crustáceos, entre otros). Con el fin de reflejar su alcance global en 2007 EUREPG.A.P cambió su nombre a GLOBALG.A.P.
El grupo del proyecto FIL/FAO del Comité permanente de la FIL (2012) desarrolló “La Guía de Buenas Prácticas en Explotaciones Lecheras”, que se adapta a la producción de leche de distintas especies. La Guía se centra en la relación entre la seguridad de los consumidores y la gestión económica, social y ambiental a nivel de la explotación. Ofrece una orientación proactiva para el logro de esos objetivos en las explotaciones. Las prácticas que se sugieren se han preparado a partir de directrices sobre las mejores prácticas y los sistemas de aseguramiento existentes en el mundo y, por ello, algunas variarán en su aplicabilidad en las distintas regiones lecheras. No pretende ser jurídicamente vinculante y se anima a los lectores a seleccionar y aplicar las directrices que son pertinentes en su situación.
A su vez, el grupo de trabajo en el que me desenvuelvo ha desarrollado herramientas de calidad y bienestar animal, de fácil implementación. Se aunaron esfuerzos y criterios de distintas instituciones y sectores de la producción para obtener herramientas consensuadas que respondan a las necesidades de los productores. Es así como a través del trabajo en red con el Instituto Nacional de Tecnología Agropecuaria (INTA) y otras instituciones de Argentina, Chile y Uruguay se elaboraron herramientas de BP y de bienestar animal para sistemas ganaderos incluyendo tambos bovinos y caprinos, con sus correspondientes aplicaciones (Apps) (Consigli et al. 2009, Aimar et al. 2010, Negri et al. 2013, Scaltritti et al. 2013, Sirven et al. 2015, Negri et al. 2016, Negri et al. 2019).
A continuación se describe la Guía de Buenas Prácticas para Establecimientos Lecheros; Material de referencia de la Red Buenas Prácticas Agropecuarias (Negri et al. 2019). El INTA, la Facultad de Ciencias Agropecuarias de la Universidad Nacional de Córdoba (FCA-UNC) y la Asociación Pro Calidad de Leche y sus Derivados (APROCAL) trabajaron desde el año 2010 en un plan cuyo objetivo fue desarrollar una Guía de BP consensuada por diferentes representantes del sector lechero y validada en sistemas reales de producción. El plan constó de dos etapas. En primer lugar, se trabajó en el desarrollo de la Guía de Buenas Prácticas Tamberas (BPT) donde se convocó a expertos, referentes y demás actores claves del sector de Argentina para consensuar el material técnico sobre el cual se basarían las demás etapas. La herramienta se desarrolló sobre las directrices de FAO (2012) y los conocimientos de los profesionales involucrados. Como resultado se obtuvo una Guía consensuada en la cual se brindan recomendaciones de BPT (Negri et al. 2013) para maximizar la producción y la calidad de leche en sistemas sustentables mediante un material claro y de fácil interpretación. Está organizada en seis capítulos: Ordeño e higiene, Sanidad animal, Alimentación, Ambiente, Bienestar animal
153 PRODUCCIÓN SUSTENTABLE EN GANADERÍA
y Condiciones del trabajo y de los trabajadores. Incluye una lista de chequeo para auditorías y anexos.
La segunda etapa (2013-2015) fue la validación de la Guía a Campo. Con los resultados de esa validación se desarrolló una nueva versión de la herramienta (Negri et al. 2016). En el año 2018, la Guía fue revisada y adoptada como Material Referente de la Red de BPA de Argentina lográndose otro documento (Negri et al. 2019), disponible en las páginas web del INTA (http:// inta.gob.ar), APROCAL (http://aprocal.com.ar) y del Observatorio de la Cadena Láctea Argentina (http://www.ocla.org.ar).
Para procesar y analizar los datos relevados con la Guía se desarrolló una App para PC, denominada Cheq Tambo (Negri y Aimar 2017), que permite visualizar gráficamente la situación global del establecimiento y el listado de no cumplimientos, identificar causas de falla en el sistema y priorizar las acciones de mejora. En la Figura 2, se puede observar como Cheq Tambo muestra los resultados por áreas o capítulos en formato grafico de torta.

Figura 2. Cheq Tambo muestra en gráficos, los resultados de cumplimientos y no cumplimientos por áreas o capítulos.
Esta información es importante porque permite visualizar fácilmente cuál de las áreas está en peores condiciones en el sistema productivo y facilita
154 DESARROLLO SOSTENIBLE
la toma de decisiones para la mejora. El valor agregado de esta herramienta es el consenso logrado entre numerosas instituciones, la App para el relevamiento y procesamiento de datos y la libre disponibilidad de ambas en la web. Además, recientemente se desarrolló un curso on line sobre la guía de libre disponibilidad en la plataforma Anpro Campus (2019). Los invito a que realicen el curso gratuito de Buenas Prácticas Tamberas disponible on line en la plataforma Anpro Campus y que implementen la guía en sus establecimientos lecheros utilizando la App Cheq Tambo. Después de haber presentado algunas alternativas de libre disponibilidad para capacitarse y trabajar en BP en los sistemas ganaderos, a continuación se presentan algunas recomendaciones de BP generales y de fácil implementación.
2. RECOMENDACIONES DE BUENAS PRÁCTICAS EN LAS INSTALACIONES
2.1 Callejones y vías de tránsito interno
Las vías o callejones por donde los animales transitan, deben mantenerse en buen estado y conservación para disminuir el riesgo de lesión en los animales. Se debe evitar el anegamiento, obstáculos y la formación de barro para minimizar el estrés de los animales. Se deben dimensionar de manera tal que permitan el adecuado traslado de los animales, evitando el amontonamiento que genera estrés. Se recomienda que el ancho esté en función al tamaño del rodeo. Además, los cambios de dirección deben hacerse mediante curvas suaves para que el ganado pueda distinguir hacia donde va. En la Figura 3, se muestran ejemplos adecuados e inadecuados sobre estos aspectos.



Figura 3. Ejemplos de callejones en buenas (A) y malas condiciones (B). Trazado inadecuado por ser construido con ángulos de 90° (C) (Aimar et al. 2010).
155 PRODUCCIÓN SUSTENTABLE EN GANADERÍA
C A B
2.2 Alambrados
Los alambrados deben estar en buen estado de mantenimiento, limpieza y conservación. No debe utilizarse alambre de púa. Las ataduras y uniones de alambres no deben presentar puntas libres ya que pueden causar lastimaduras en los animales (Fig. 4).




Figura 4. Alambrados en buen (A) y mal (B) estado de mantenimiento y limpieza. Buenas (C) y malas (D) ataduras de alambres (Aimar et al. 2010).
2.3 Provisión de agua
Los bebederos y tanques australianos deben ubicarse estratégicamente para que todos los animales tengan acceso a agua limpia, fresca a voluntad y deben mantenerse en buen estado de conservación. Sus dimensiones deben ser las adecuadas para el tamaño del rodeo del establecimiento Periódicamente debe realizarse la limpieza de los depósitos de agua, como así también mantener libres de malezas sus alrededores. El suministro
156 DESARROLLO SOSTENIBLE
B
D C
A
de agua debe ser permanente y de calidad. Una forma práctica para ver si el caudal de agua es suficiente, es observar que, cuando las vacas estén bebiendo, el nivel del agua en el bebedero llegue hasta una altura de ¾ del mismo. Para evitar el anegamiento y el barro próximo a los bebederos se aconseja realizar un piso de cemento (Fig. 5A), lo que evita situaciones como la que se puede observar en la imágen de la Figura 5B.


Figura 5. Bebederos con piso de cemento correcto (A) y bebederos con piso inadecuados (B) (Aimar et al. 2010).
2.4 Comederos
Los comederos deben estar construidos, diseñados, dimensionados y ubicados de manera tal que garanticen la disponibilidad del alimento a todas las vacas, evitando el estrés por el acceso restringido a la ración; para ello es necesario asignar no menos de 60 cm de frente de comedero por animal (Aimar et al. 2010). Se recomienda implementar una rutina de limpieza de los comederos, retirando todo resto de alimento que no esté en condiciones para su consumo y residuos que se puedan encontrar en su interior. En la Figura 6, se observan distintos tipo de comederos construidos con diferentes materiales, algunos con diseños inapropiados que pueden lastimar a los animales y otros donde se desperdicia mucho alimento.
2.5 Mangas y cargaderos
Estas instalaciones deben tener pisos adecuados (antideslizantes), preferiblemente de cemento con ranuras. La construcción de sus paredes o laterales debe ser de tipo compacto o cerrado, sin presentar luz entre las tablas. Además, deben mantenerse en buen estado de mantenimiento y conservación.
157 PRODUCCIÓN SUSTENTABLE EN GANADERÍA
A B




Figura 6. Distintos tipos de comederos (A-B) construidos con diferentes materiales. Los tipos C y D puede lastimar a los animales (Aimar et al. 2010).
2.6 Otras recomendaciones generales para instalaciones
• De poseer un sistema con animales encerrados, ya sea todo el día o parte de él, el lugar de encierre debe permitir que todas las vacas puedan estar echadas simultáneamente, rumiar y levantarse sin dificultad;
• Proveer sombra adecuada y suficiente a los animales para otorgarles protección y confort. La misma va a depender del tipo de sistema productivo. En el caso del corral de espera u ordeño en establecimientos lecheros, se aconseja también ventilación y aspersión. Pueden verse ejemplos de sombras en la Figura 7;
• Realizar una rutina de evacuación de estiércol y purines que permita mantener en condiciones adecuadas de limpieza de las instalaciones como corrales de alimentación, de espera u ordeño o donde se alojen los animales en forma parcial o permanente. Se debe poseer un plan de gestión de purines;
• Evitar que el ganado se encuentre expuesto a fuentes externas de estrés como barro, ruido excesivo, descargas eléctricas dispersas, presencia de otros animales o a un manejo inapropiado (con gritos, látigos o picanas) que pueda causarles malestar. La presencia de perros no es buena para el bienestar de las vacas por ser depredadores naturales.
158 DESARROLLO SOSTENIBLE A B C D


A B C

Figura 7. Tipo adecuado (A-B) e inadecuado (C) de sombra (Aimar et al. 2010).
3. ALIMENTACIÓN
Es importante que los alimentos se encuentren disponibles en forma segura y accesible, para lo cual se debe contar con instalaciones que maximicen el bienestar de las vacas. Para aumentar la producción es fundamental mantener a la vaca bien alimentada (Fig. 8), limpia, seca y cómoda las 24 horas del día (Fig. 9).

A B

Figura 8. Distintas alternativas de instalaciones para corrales de alimentación (A-B). En la foto de la derecha (B) se puede observar instalaciones con piso de tierra suelto con altas probabilidades de tornarse barroso en días de lluvias (Aimar et al. 2010).
Se debe contar con un plan de alimentación que debe ser revisado periódicamente por un profesional. La cantidad y calidad deben estar en función de la edad, crecimiento, peso corporal, estado de lactación, nivel de producción, preñez y actividad física. En rodeos lecheros de alta producción, hay que realizar un adecuado manejo de las vacas en transición.
159 PRODUCCIÓN SUSTENTABLE EN GANADERÍA


Figura 9. Ganado vacuno en sistemas pastoriles. Algunos pastorean, mientras otros realizan actividades pudiendo manifestar su comportamiento natural (Aimar et al. 2010).
Se deben respetar las tecnologías y prácticas de confección de silos y de henos y controlar las condiciones de su almacenamiento. Se recomienda realizar un análisis de calidad a los alimentos antes de comenzar un nuevo lote, por ejemplo temperatura, pH, olores extraños, humedad, color, olor y presencia de hongos.
Se deben llevar registros de compra de alimentos (archivo de factura). Los mismos deben incluir el tipo de alimento, cantidad, fecha de entrega y proveedores. Los alimentos deben almacenarse en condiciones que eviten su deterioro o contaminación ya sea por el sol, el agua de lluvia o por condiciones que favorezcan la proliferación de hongos. Es imprescindible, además, realizar un control de plagas y roedores en los lugares de almacenamiento.
Las aplicaciones de productos químicos en pasturas o cultivos forrajeros deben realizarse bajo la supervisión de un profesional y según legislación vigente. Además se deben registrar todas las aplicaciones de productos químicos realizados a las pasturas y cultivos forrajeros y asegurarse que los períodos de espera sean respetados rigurosamente.
4. SANIDAD
Todos los establecimientos ganaderos deberán llevar un plan sanitario implementado y supervisado por un profesional. Dicho plan debe comprender todos los tratamientos obligatorios dispuestos por la autoridad sanitaria nacional y aquellos sugeridos, en función de la región donde se hallen, que aseguren una correcta sanidad del ganado. Los animales deben ser identificados por un método seguro. Se debe disponer de procedimientos escritos para la detección y manejo de los animales
160 DESARROLLO SOSTENIBLE
A B
enfermos y registrar las actividades sanitarias, diagnósticos realizados, tratamientos indicados y el período de carencia. Los antibióticos se deben utilizar bajo la supervisión de un profesional, respetando las indicaciones, las dosis y de manera rigurosa, los periodos de carencia. Todo trabajador que maneje y aplique medicamentos tiene que tener formación y conocimientos al respecto. Cuando se deba realizar un tratamiento sanitario a un vacuno, es importante manejarlo acompañado de otros congéneres, de esta manera se facilitará el trabajo y se conseguirá que esté más tranquilo. Se torna muy difícil manejarlo aislado dada su característica de ser un animal de manada (Fig. 10).


Figura 10. Puede observarse las dos situaciones de manejo del bovino en grupo (A) y solo (B). Cuando se lo maneja solitariamente, el animal no se dirige a donde se lo que quiere llevar, intentando huir en otro sentido (Aimar et al. 2010).
Para los sistemas lecheros se sugieren, además, implementar un programa preventivo de control de mastitis (Negri et al. 2019) como así también algunas de las siguientes prácticas:
• Llevar un registro de las vacas tratadas con antibióticos que contengan al menos la fecha de la aplicación, identificación de la vaca, el diagnóstico, el antibiótico empleado y el tiempo de carencia para evitar la aparición de residuos de antibióticos en leche;
• Marcar todos los animales que han sido tratados para que puedan ser reconocidos por los ordeñadores y su leche sea descartada. Esto puede llevarse a cabo mediante: pintura en las patas o pintura en la ubre;
• Separar las vacas tratadas del resto del rodeo lechero, idealmente en un rodeo sanitario, y ordeñarlas al final;
• Llevar registros actualizados;
• Guardar los medicamentos en un lugar seguro, con acceso restringido y en condiciones ambientales óptimas para su conservación;
161 PRODUCCIÓN SUSTENTABLE EN GANADERÍA
A B
• Implementar registros de uso y almacenamiento de los antibióticos;
• Identificar y separar claramente los medicamentos vencidos, no reutilizar los envases vacíos de los medicamentos y asegurar la correcta eliminación de estos.
5. BIENESTAR ANIMAL (BA) y LA SUSTENTABILIDAD
Como se expresara anteriormente la ganadería es muy importante tanto para la seguridad alimentaria como para la supervivencia de muchos pequeños y medianos productores. En estos sistemas, el bienestar animal cobra vital importancia y es, además, uno de los objetivos de las BPP para la sustentabilidad. Según Paranhos da Costa (2018), el bienestar animal también puede ser considerado como un elemento central del concepto de sostenibilidad, ya que influye y es influenciada por cada uno de los tres pilares de la sostenibilidad: la preocupación por la preservación de los recursos naturales, el mantenimiento de comunidades saludables y la promoción de la vitalidad económica.
Es sabido que en animales estresados se producen cambios fisiológicos, metabólicos y de comportamiento que, entre otros efectos, se inmunodeprimen y disminuyen el consumo afectando negativamente su producción, y enfermándose más, lo que impacta negativamente en la productividad y en la sustentabilidad de los sistemas. Dada la importancia del BA, en esta parte del capítulo se dedicará especial atención a conceptos e indicadores relacionados al bienestar animal que ayuden a mejorar nuestros sistemas. El término bienestar animal (OIE 2019) designa el estado físico y mental de un animal en relación con las condiciones en las que vive y muere. Un animal experimenta un buen bienestar si está sano, cómodo, bien alimentado, en seguridad, y si no padece sensaciones desagradables como dolor, miedo o desasosiego y es capaz de expresar comportamientos importantes para su estado de bienestar físico y mental. Los distintos tipos de incomodidades que puede sufrir el bovino le producen un mayor o menor grado de estrés, entendiéndose por éste la adecuación del organismo a las distintas agresiones físicas o psicológicas a las que es sometido (Consigli et al. 2009). Desde hace ya muchos años, la Comisión Brambell (1965) describió las “cinco libertades”, o derechos de los animales domésticos, como la capacidad de poder fácilmente “darse vuelta, asearse, levantarse, acostarse y estirarse”. La World Veterinary Association, en 1989, adoptó sus propios cinco derechos, aplicados a todas las especies y basados sobre los del Consejo Británico de Bienestar para los Animales de Granja (Webster 1987). Años más tarde, Mellor y Reid (1994) propusieron el modelo de los “5 dominios del bienestar animal” como una alternativa para realizar evaluaciones sistemáticas del bienestar de los animales de producción (Fig. 11).
162 DESARROLLO SOSTENIBLE

D1: NUTRICIÓN
Hambre, sed y desnutrición

D5: ESTADO MENTAL
Libre de miedo y angustia


D4: COMPORTAMIENTO

Posibilidad de manifestar su comportamiento natural
D2: AMBIENTE
Cambios ambientales

Confort físico y térmico

D3: SALUD
Libre de dolor, Enfermedad y lesiones
Figura 11. Los 5 dominios del bienestar animal (adaptado de Mellor y Reid 1994, Brambell 1965).
Tanto el bienestar, como el estrés en el ganado se pueden ver y medir a través de indicadores del comportamiento, fisiológicos y/o bioquímicos posibilitando implementar acciones que procuren mayor bienestar y que minimicen o eviten el estreés. Una de las problemáticas detectadas en proyectos I+D llevados a cabo por nuestro grupo de trabajo, en los sistemas de producción ganadera en general, es la falta de medición de indicadores con una metodología estandarizada. Es necesario definir “qué es un indicador” y las características que debe reunir. Un “Indicador” es un dato o conjunto de datos que ayudan a medir objetivamente, un estado, la evolución de un proceso o de una actividad. En cuanto a las características de los indicadores, según Manteca (2011) debieran ser válidos, fiables y prácticos. Entendiéndose por Válidos, que midan lo que tengan que medir, Fiables, que tengan alta correlación entre mediciones y observadores y Prácticos, que no requieran mucho tiempo ni material. Son muchos los indicadores relativos al estrés que pueden medirse con distinta complejidad en el campo. Algunos requieren toma de muestra de sangre para su posterior análisis en laboratorio, toma de temperatura rectal o simplemente observación visual. En la Figura 12, se detallan algunos de los indicadores sugeridos en distintos protocolos (Welfare Quality® 2007, Sirven et al. 2015) que fácilmente pueden relevarse a campo para evaluar el bienestar animal y que brindan información muy importante en cuanto al estrés generado por problemas en el establecimiento.
163 PRODUCCIÓN SUSTENTABLE EN GANADERÍA






CONDICIÓN COrPOrAL
QUÉ SE OBSERVA:
El grado de engrasamiento, indicador de las reservas corporales del animal
QUÉ NOS INDICA:
Si los animales sufren hambre o problemas nutricionales
EVALUACIÓN DE LA BOSTA
QUÉ SE OBSERVA:
La consistencia y forma de la bosta
QUÉ NOS INDICA:
El equilibrio nutricional del bovino
EVALUACIÓN DEL MIEDO - DISTANCIA DE HuIDA
QUÉ SE OBSERVA:
La distancia mínima a la que una persona puede acercarse a las Vacas.
QUÉ NOS INDICA:
La relación humano-animal. El nivel de estrés que genera el manejo por parte de los operarios
SCOrE DE LOCOMOCIÓN
QUÉ SE OBSERVA:
El apoyo de los miembros y la curvatura del lomo.
QUÉ NOS INDICA:
Presencia de rengueras en los animales, por lo tanto, dolor y estrés
SuCIEDAD DE MIEMBrOS Y DE uBrES
QUÉ SE OBSERVA:
Presencia de placas de suciedad y/o barro
QUÉ NOS INDICA:
El grado de estrés que sufren los animales por encontrarse en instalaciones inadecuadas
BOSTEO EN LA SALA DE OrDEÑO
QUÉ SE OBSERVA:
Cantidad de vacas que bostean en la sala de ordeño
QUÉ NOS INDICA:
Si los animales sufren miedo o dolor al momento del ordeño y/o han tenido experiencias negativas dentro de la instalación
Figura 12. Indicadores para evaluar el bienestar animal.
164 DESARROLLO SOSTENIBLE
Tan importante es medir indicadores para conocer el estado de bienestar de nuestro ganado, como el hacerlo de una manera correcta. Para ello es imprescindible contar con una metodología sistematizada de medición y realizarlo sobre la totalidad de los animales o, en su defecto, en una muestra representativa para que los resultados sean válidos. En ese sentido, existe numerosa bibliografía que da cuenta de cómo realizarlo (Bavera y Peñafort 2006, Welfare Quality® 2007, IPCVA 2009, Sirven et al. 2015, Zimpro 2015). Hasta aquí se han desarrollado sólo algunos aspectos relevantes y generales en cuanto a las estrategias para una ganadería sustentable, es imposible en estas páginas incluir un exhaustivo análisis de las mismas. Por ello se pretendió brindar algunos fundamentos claves junto a herramientas disponibles para que, a quienes les interese, puedan profundizar en el tema e incluso implementar algunas de las estrategias aquí presentadas. Cualquiera de ellas, o parte de las mismas, que se comiencen a implementar ayudará a iniciar el camino de la sustentabilidad y de CSA, por mínimo que parezca. Para ir cerrando el capitulo y a manera deguía en la Figura 13, se esquematiza un posible plan de implementación de BP a seguir para trabajar en un ciclo de la mejora continua.
Elección de protocolo o herramienta
jornadas con asesores facilitadores
Capacitación a nivel de tambos
Auditoría inicial
CICLO DE MEjORA CONTINUA
Monitoreo
Implementación de la herramienta
Lista de no conformidades priorización
Puesta en marcha de acciones de mejora. Capacitación
Autocontrol
Capacitación, puesta en marcha de acciones de mejora
Nuevo ranking de no conformidades
Figura 13. Esquema de plan de implementación para algún protocolo o herramienta de BP.
165 PRODUCCIÓN SUSTENTABLE EN GANADERÍA
CONSIDErACIONES FINALES
Hasta aquí se han desarrollado sólo algunos aspectos relevantes y generales en cuanto a las estrategias para una ganadería sustentable, es imposible en estas páginas incluir un exhaustivo análisis de las mismas. Por ello se pretendió brindar algunos fundamentos claves junto a herramientas disponibles para que, a quienes les interese, puedan profundizar en el tema e incluso implementar algunas de las estrategias aquí presentadas. Cualquiera de ellas, o parte de las mismas, que se comiencen a implementar ayudará a iniciar el camino de la sustentabilidad y de CSA, por mínimo que parezca.
Finalmente, los invito a transitar este camino de las Buenas Prácticas que no es más ni menos que el camino de la Sustentabilidad.
REFERENCIAS BIBLIOGRÁFICAS
Aimar MV, Consigli RI, Cravero BF, Rosmini MR (2010) Bienestar animal: Manual de Buenas Prácticas Pecuarias para establecimientos productores de leche y carne bovina de base pastoril Universidad Católica de Córdoba y Agencia de Cooperación Internacional de Japón, 277p. Anpro Campus (2019) Curso e-learning en Buenas Prácticas para establecimientos lecheros. https://www.anprocampus.com. Acceso Abril de 2019. Bavera G, Peñafort C (2006) Lectura de la bosta del bovino y su relación con la alimentación. Cursos de produccion bovina de carne, FAV-UNRC, 9p. Brambell FWR (1965) Report of the technical committee to enquire into the welfare of animals kept under intensive livestock husbandry systems. Her Majesty’s Stationery Office, London, 89p. Campbell BM, Thornton P, Zougmoré R, Van Asten P, Lipper L (2014) Sustainable intensification: What is its role in climate smart agriculture? Current Opinion in Environmental Sustainability, 8:39–43. Casasola, (2019) Experiencias en América Latina y el Caribe sobre buenas prácticas ganaderas.https://www.catie.ac.cr/catie-noticias/3762-participeen-el-webinar-experiencias-en-america-latina-y-el-caribe-sobre-buenaspracticas-ganaderas.html. Acceso Abril de 2019.
Consigli RI, Aimar MV, Cravero BF, Rosmini MR (2009) Bienestar animal: Manual de Buenas Prácticas Pecuarias para establecimientos productores de ganado bovino de carne de base pastoril Universidad Católica de Córdoba y Ministerio de Agricultura, Ganadería y Alimentos del gobierno de la provincia de Córdoba, 288p.
Elanco Animal Health (2009) The 5 point body condition scoring system. https://cmapspublic3.ihmc.us/rid=1QKSXD992-1V9KW6Q-292P/ai10752body-condition-score-insert.pdf. Acceso Abril de 2019.
166 DESARROLLO SOSTENIBLE
FAO (2017a) The future of food and agriculture trends and challenges. http:// www.fao.org/3/a-i6583e.pdf. Acceso Abril de 2019.
FAO (2017b) Soluciones ganaderas para el cambio climático. http://www.fao. org/3/I8098ES/i8098es.pdf. Acceso Abril de 2019.
FAO y FIL (2012) Guía de buenas prácticas en explotaciones lecheras. Directrices
FAO: Producción y Sanidad Animal, 8, Roma, 51p.
FAO (2010) Climate-smart agriculture Sourcebook.http://www.fao.org/3/ i3325e/i3325e.pdf. Acceso Agosto de 2019.
FAO (2006) Livestock’s long shadow: environmental issues and options. Rome. http://ftp.fao.org/docrep/fao/010/A0701E/A0701E00.pdf. Acceso Abril de 2019.
Gerber PJ et al. (2013) Tackling climate change through livestock – A global assessment of emissions and mitigation opportunities. Food and Agriculture Organization of the United Nations (FAO), Rome, 139p.
Guerra C, Gallardo M, Castro H (2019) https://inta.gob.ar/sites/default/files/ script-tmp-de la bosta a la nutricion.pdf. Acceso Abril de 2019.
GLOBALGAP (2018) https://www.globalgap.org/. Acceso Abril de 2019.
IPCVA (2009) Instituto de Promoción de la Carne Vacuna Argentina Cuadernillo técnico. Condición corporal en la ganadería de cría. http://www.ipcva.com. ar/files/ct08.pdf. Acceso Abril de 2019.
Lipper L et al. (2014) Climate-smart agriculture for food security. Nature Climate Change, 4(12):1068–1072. doi:10.1038/nclimate2437.
Manteca X (2011) El protocolo Welfare Quality en vacuno de leche. Indicadores de Bienestar animal. http://www.aprocal.com.ar/wp-content/uploads/ Bienestar-Animal-Xavier-Manteca-Mayo-2011.pdf. Acceso Abril de 2019.
Mellor DJ, Reid CSW (1994) Concepts of animal well-being and predicting the impact of procedures on experimental animals. In: Improving the Well-being of Animals in the Research Environment. Proceedings of the conference held at the Marriott Hotel, Sydney, ANZCCART, pp 3-18.
Moreira D, Castro C (2016) Lechería climáticamente inteligente adaptación y mitigación en el trópico húmedo (Nº IICA L01), IICA, San José (Costa Rica) Unión Europea, Madrid (España), 12p.
Negri L et al. (2013) Guía de Buenas Prácticas en el Tambo, compilado por Livia Negri; María Verónica Aimar. INTA, Buenos Aires, 87p.
Negri L et al. (2016) Guía de buenas prácticas para tambos; compilado por Livia Negri; María Verónica Aimar. INTA Buenos Aires, 71p.
Negri L, Aimar MV (2017) Cheq Tambo. Aplicación para procesar datos del sistema productivo de leche generados con la utilización guía BPT. Registro propiedad RE-2017-16575947. Titular: INTA.
Negri L et al. (2019) Guía de buenas prácticas para establecimientos lecheros: material de referencia de la Red de BPA; compilado por Livia Negri; María Verónica Aimar. https://inta.gob.ar/sites/default/files/librec9915 negri guia bpl establecimientos lecheros digital v6.pdf Acceso Agosto 2019.
167 PRODUCCIÓN SUSTENTABLE EN GANADERÍA
Paranhos da Costa MJR (2018) Bienestar animal y sistemas sostenibles para la producción ganadera. 6º Congreso de la Asociación Uruguaya de Producción Animal. https://www.produccion-animal.com.ar. Acceso Abril de 2019.
Sarandon SJ (2002) El desarrollo y uso de indicadores para evaluar la sustentabilidad de los agroecosistemas. Agroecología el camino hacia la agricultura sustentable, E.C.A, La Plata, Argentina, 22p.
Scaltritti MR, Aimar MV, Chavez MS (2013) “Guía MILC: Guía Metodológica para la inocuidad de leche caprina”, INTA, 100p.
Sirven MH, Aimar MV, Martínez Luque L et al. (2015) “Cuadernillo de bienestar animal: guía de evaluación del bienestar de vacas lecheras en producción en el ámbito de las instalaciones de ordeño”. Asociación pro Calidad de Leche (APROCAL), Buenos Aires, 32p.
Tommasino H, Garcia Ferreira R, Marzoli J, Gutierrez R (2012) Indicadores de sustentabilidad para la producción lechera familiar en Uruguay: análisis de tres casos. Agrociencia Uruguay, 16(1):166-176.
Webster AJF (1987) Meat and right: farming as if the animal mattered. Canadian Veterinary Journal, 28(8):462-465.
Welfare Quality® (2013) http://www.welfarequality.net/en-us/reports/ assessment-protocols/. Acceso Abril de 2019.
Zinpro (2015) Locomotion Scoring of Dairy Cattle. https://www.zinpro.com/ lameness/dairy/locomotion-scoring. Acceso Abril de 2019.
168 DESARROLLO SOSTENIBLE
REPENSANDO LOS TERRITORIOS PARA GENERACIÓN DE BIOENERGÍA
Gabriela Cristiano1 & Marianela De Batista2
1 Universidad Nacional del Sur (UNS), Departamento de Economía, Instituto de Investigaciones Económicas y Sociales del Sur (IIESS/CONICET), San Andrés 800, Campus Altos del Palihue, (8000) Bahía Blanca, Argentina. E-mail: gcristiano@uns.edu.ar
2 Universidad Nacional del Sur (UNS), Departamento de Ciencias de la Administración, San Andrés 800, Campus Altos del Palihue, (8000) Bahia Blanca, Argentina. E-mail: marianela.debatista@uns.edu.ar
INTRODUCCIÓN
La preocupación por el medio ambiente a nivel mundial ha comenzado a manifestarse desde hace aproximadamente cuatro décadas, formando parte de la agenda del sector público y numerosos organismos de carácter internacional. Esto conllevó a repensar el análisis integral de los territorios, considerando, entre otros aspectos, los impactos ambientales negativos que las actividades productivas que se insertan en él traen aparejados. La contaminación del aire, del suelo y del agua atentan contra la productividad del sistema, perjudicando a las generaciones futuras y a la sostenibilidad del territorio.
En nuestro país, los procesos de reestructuración y relocalización de diversas actividades productivas se han ido manifestando en los últimos tiempos. Estos procesos fueron acompañados de un marco institucional propicio, el cual pone como tema prioritario en la agenda pública el cuidado del medioambiente y la diversificación de la matriz energética nacional, impulsando la generación de energía renovable.
Teniendo como marco de referencia el enfoque del Desarrollo Territorial Rural se presentan los antecedentes legales que promueven la generación de bioenergía en Argentina a partir del tratamiento de los residuos orgánicos provenientes del sector primario y de la agroindustria. Finalmente, se exponen algunos ejemplos considerando los proyectos seleccionados en el programa RenovAr (Ronda 1 y 2), lo que permite visualizar nuevas actividades que contemplan la producción de bioenergía.
El programa RenovAr tiene carácter nacional y busca promover la generación de energías renovables, para ser sumadas a la oferta eléctrica del país. Básicamente consiste en un proceso de convocatoria abierta para la contratación en el Mercado Eléctrico Mayorista (MEM) de energía eléctrica de fuentes renovables.
Stadnik MJ, Velho AC, Zorrilla SE (eds.) Desarrollo Sostenible en la Producción Agroalimentaria
169
10
1. MARCO DE REFERENCIA: EL DESARROLLO TERRITORIAL RURAL (DTR)
A nivel mundial, durante la década del ´90 produjeron una serie de cambios, los cuales fueron el resultado de las políticas neoliberales, tales como desregulación, privatizaciones e integración regional. Esto ha influido en Latinoamérica para repensar a los territorios y analizar a las regiones desde un contexto globalizado. Surgieron así autores que comenzaron a abocarse al estudio de esta problemática (Shejtman y Berdegué 2004). Es en este sentido que el proceso de globalización ha contribuido a revalorizar los espacios territoriales, dando origen a nuevas formas de producción y de relacionar espacios socio-económicos.
Este hecho ha brindado la posibilidad para que cada territorio o región, a los que se les reconoce su heterogeneidad, desarrollase sus propias capacidades y pudiese integrarse a nuevos territorios (Manzanal et al. 2007). Es recién a partir de estos acontecimientos históricos que la literatura económica comienza a incorporar la noción de espacio o territorio “(…) en torno a la tarea de dilucidar los factores que explican o determinan los procesos de concentración de actividades productivas y de servicios en determinados espacios (ciudades), como los que conducen a que determinadas localizaciones exhiban un mayor dinamismo y capacidad competitiva que otras” (Schejtman y Berdegué 2006).
Surge así el Desarrollo Territorial Rural (DTR), que se define como un proceso de transformación que contempla no sólo aspectos tecno-productivos sino que, además, considera el contexto institucional en un espacio rural específico con el propósito final de reducir la pobreza rural. Los procesos de transformación territorial en términos productivos tienen como objetivo generar conexiones entre ese espacio con otros territorios más desarrollados y dinámicos a los efectos de generar nuevas redes comerciales y de cooperación, incrementar la competitividad e involucrar a los agentes intra territorio con otros ajenos al mismo (Schejtman y Berdegué 2004). Desde este nuevo enfoque del DTR se entiende al territorio no sólo como un espacio físico o geográfico sino como “una construcción social; es decir, un conjunto de relaciones sociales que dan origen y a la vez expresan una identidad y un sentido de propósitos compartidos por múltiples agentes públicos y privados” (Shejtman y Berdegué 2004). Aparece aquí entonces un concepto de desarrollo rural más amplio, de índole multisectorial, en el que se incorpora la noción de territorio que abarca cuatro dimensiones estratégicas: la económica-productiva, la sociocultural, la ambiental y la política-institucional.
Según el Instituto Nacional de Tecnología Agropecuaria (INTA 2007), si se pretende seguir el enfoque del DTR, en primer lugar debe definirse qué se entiende por territorio. En este sentido puede considerarse como territorio a un espacio geográfico, el cual se encuentra caracterizado por una base de recursos naturales específica, con una identidad propia producto de su historia
170 DESARROLLO SOSTENIBLE
y cultura local, conformado por un entramado socio-institucional, producto de los vínculos entre los actores e instituciones que lo conforman y por determinadas formas de producción, intercambio y distribución de la renta. Estas características le dan identidad a un territorio, que lo convierten en una construcción social, consecuencia de las interrelaciones y decisiones de los actores locales en torno a un proyecto que los nuclea. Por lo tanto, es posible entender al desarrollo territorial como un proceso impulsado por sus actores que busca fortalecer sus capacidades locales aprovechando recursos propios y externos, consolidando el entramado socio-institucional y el sistema económico-productivo y mejorando las condiciones de vida de su comunidad (INTA 2007).
INTA (2007) y Schejtman y Berdegué (2004) señalan, tal como lo indica la literatura referida al desarrollo territorial, que éste se conforma con diferentes elementos, a saber:
La participación social: hace referencia a que el desarrollo es una construcción social que demanda del compromiso y la participación activa de todos los actores para lograr que sea equitativo y sostenible en el tiempo. Es decir, el territorio es un conjunto de relaciones sociales que dan origen y expresan una identidad y un sentido de propósitos compartidos por múltiples agentes públicos y privados.
La multidimensionalidad: múltiples dimensiones interactúan en un territorio, delineando las características de esa realidad socio-espacial, a saber: 1) Dimensión sociocultural: busca fortalecer la identidad y el capital social del territorio, en pos de lograr la equidad en la distribución de recursos; 2) Dimensión económica-productiva: busca lograr la competitividad de las actividades económicas, sean productivas o no; 3) Dimensión ambiental: su objetivo principal es la sustentabilidad, mediante la implementación de un proceso de desarrollo sostenible, que es aquel capaz de satisfacer las necesidades de la generación presente sin comprometer la capacidad de las generaciones futuras para atender a sus propias necesidades; 4) Dimensión política-institucional: la misma busca garantizar la gobernabilidad, la capacidad de los actores de garantizar una gestión democrática de la sociedad local.
La multisectorialidad: busca favorecer la mirada integral del territorio, lo que implica en términos económicos la complementariedad entre actividades agropecuarias y no agropecuarias en la generación de ingresos, estableciendo un fuerte vínculo entre agricultura-industria-servicios, incluyendo actividades económicas de múltiples sectores a los fines de lograr la integración de servicios en el desarrollo del territorio. Se debe asegurar la oferta territorial de infraestructura, equipamientos básicos y servicios, para garantizar la permanencia de la población en el medio rural.
La visión de una economía de territorio: lleva a asumir la multisectorialidad de la economía de los territorios rurales, que implica la consideración de todas las actividades, productivas o no, que generan ingresos para las familias rurales, en base a la valorización de los recursos locales. Se reconoce la
171 REPENSANDO LOS TERRITORIOS
importancia de las cadenas de valor representadas por los clusters, las cadenas agroalimentarias y agroindustriales territorializadas, las denominaciones de origen, el turismo rural y la agroindustria artesanal, entre otros.
La búsqueda de una mayor coincidencia institucional: la nueva institucionalidad se refiere a aquellas instituciones (formales o informales) creadas a partir del proceso de desarrollo que reflejan el nivel de concertación alcanzado por los actores del territorio y aseguran la sostenibilidad, en el tiempo, de las estrategias y acciones acordadas. Es decir, el desarrollo institucional se vincula directamente con la existencia y funcionamiento de redes de relaciones sociales de reciprocidad basadas en la confianza, elementos culturales e identidades territoriales y redes con actores externos al territorio, lo que facilita el aprendizaje colectivo. Busca facilitar la cooperación para competir, suponiendo que los incentivos generados por los mercados y el gobierno sean conducentes a incrementar las capacidades de las comunidades rurales, acrecentando la calidad y cantidad de sus activos físicos, humanos, naturales, financieros y sociales, para mejorar sus condiciones de vida en un ambiente competitivo. A partir de los elementos definidos se podría indicar que el enfoque del DTR implica los siguientes lineamientos de acción:
• Desarrollar un enfoque de “abajo hacia arriba”, en el cual se integren y optimicen las políticas definidas a nivel nacional con el interés del territorio, reflejados en políticas integrales de desarrollo territorial. Es decir, las políticas surgen desde el propio territorio, según las demandas y necesidades de la población local y sus características propias;
• Lograr una articulación entre la dimensión rural y la urbana de modo de conformar unidades territoriales integrales, que fortalezcan la identidad local. Esta articulación es esencial para el desarrollo de actividades agrícolas y no agrícolas dentro del territorio, y por medio de éstas se opera la relación con la demanda externa a él;
• Crear, valorar o fortalecer el capital humano, social, natural, físico y económico-financiero. Estos tipos de capitales conforman el denominado capital del territorio, el cual indica los elementos que constituyen la riqueza del territorio, entendido como la búsqueda de especificidades que puedan ponerse de relieve, de modo de lograr un proyecto compartido por la comunidad que valorice los recursos naturales, sociales, culturales, económicos e institucionales de la misma;
• Dar importancia a las políticas de ordenamiento territorial, las cuales implican una profundización del proceso de descentralización donde se produce un desplazamiento de competencias, funciones y responsabilidades desde el ámbito nacional al provincial y local;
• Superar el modelo de compensación por el de cooperación, cogestión, responsabilidad compartida e inclusión económica y social. Se deben promover acciones que faciliten la construcción de estrategias territoriales de desarrollo, que busquen lograr una mayor cohesión social
172 DESARROLLO SOSTENIBLE
y territorial, un mayor flujo de inversiones hacia el medio rural y un equilibrio entre lo urbano-rural;
• Considerar a la innovación tecnológica y organizacional como promotores del desarrollo. La innovación colabora no sólo con las tecnologías de procesos e insumos sino con nuevas formas de organización, información, comunicación y financiación que apoyen el fortalecimiento del territorio. En el sistema agroalimentario las articulaciones entre el gobierno, sector productivo y comunidad tecno-científica son esenciales para la capacitación, investigación y transferencia tecnológica;
• Orientar la estrategia a la demanda externa al territorio en lo que respecta a los requerimientos del exterior respecto a los bienes y servicios que el territorio puede operar;
• Promover la gestión del conocimiento fortaleciendo las capacidades políticas-institucionales y culturales de los actores del territorio.
Surge así un conjunto de desafíos importantes que es necesario enfrentar (INTA 2007; Shejtman y Berdegué 2004):
• Formar recursos humanos para el desarrollo y capacitarlos de acuerdo a las necesidades del sistema productivo local;
• Considerar la integración económica y política, dado que en los territorios existen estructuras de concentración de poder político y económico evidenciadas en la concentración geográfica de las actividades económicas y de la población en unos pocos centros urbanos, derivando en una centralización del sistema político-institucional. Esto conlleva a consolidar un espacio de participación social y la construcción de una nueva institucionalidad que permita la equidad en la distribución de recursos y en las relaciones entre los actores;
• Fomentar la reconstrucción de la ruralidad, entendiendo que el término rural se refiere a todas las actividades que se llevan adelante en el medio rural, no sólo las agropecuarias. Considerar la cuestión ambiental y la articulación de variables ambientales, económicas y sociales para construir distintos escenarios de ordenamiento territorial que reflejen los costos y beneficio socioeconómicos asociados al uso alternativo del capital natural. La dimensión ambiental atraviesa de forma horizontal las políticas sectoriales, que deben considerar las características ambientales específicas de cada territorio;
• Participar activamente y comprometerse. Esto implica la cooperación entre los grupos sociales por medio de la autogestión y autoinstitución. Dado que existe un vínculo entre las políticas, los recursos y los sectores económicos y productivos, se requiere una nueva gestión que incorpore la responsabilidad compartida entre actores públicos y privados;
• Fomentar la política sectorial de Desarrollo Rural con miras a desarrollar la concurrencia de políticas públicas en el territorio rural.
173 REPENSANDO LOS TERRITORIOS
2. ENERGÍAS RENOVABLES y MEDIOAMBIENTE: ANTECEDENTES
La preocupación por el medioambiente a nivel mundial se remonta hacia fines de los años ´60. Puntualmente, el 1º de enero de 1970 Estados Unidos promulga la “Ley Nacional sobre Política Medioambiental” (National Environmental Policy Act – NEPA) (De la Maza 2007). Por lo tanto, evaluar el impacto ambiental que genera el sector productor se convierte en una necesidad para evitar o mitigar los efectos negativos que de él se desprenden.
Las actividades llevadas a cabo por el hombre, fundamentalmente las de carácter productivo o aquellas relacionadas con la construcción y mantenimiento de la infraestructura vigente, actúan sobre el medio ambiente. De este modo, se afectan las interrelaciones y equilibrios entre la sociedad y la naturaleza. Cuando una actividad o determinada acción produce alguna alteración en el medio –ya sea favorable o no– se dice que hay impacto ambiental, y puede recaer sobre algunos de los siguientes sistemas, los cuales están interrelacionados (Fernández-Vítora 1997): a) sistema o ambiente físico, b) sistema o ambiente socioeconómico y cultural
La biomasa residual1 es la generada a partir de la actividad humana –tal como residuos domiciliarios o aguas residuales–, o bien resultante de actividades económicas provenientes del sector agrícola, ganadero, silvícolo-forestal o agroindustrial (Di Paola 2013). Ésta puede ser sometida a un proceso biológico de digestión anaeróbica en el que numerosos microorganismos degradan la materia orgánica y dan como resultado un biocombustible: el biogás.
El aprovechamiento del biogás tiene su fundamento basado en su proceso de producción, en el que se genera conjuntamente electricidad y calor, representando una atractiva oportunidad medioambiental y tecnológica (Elías Castells 2012). De esta forma, se crea una fuente energética alternativa al combustible fósil que permite reducir el calentamiento global y el efecto invernadero, los cuales provocan drásticos cambios climáticos y en la mayoría de los casos son acompañados por importantes pérdidas económicas. “La bioenergía puede ser una solución inmediata al límite de crecimiento o desarrollo que tiene una gran región del país por falta de energía, ya sea aprovechando residuos pecuarios, urbanos o agroindustriales o generando cultivos energéticos para ese fin. El acceso a la energía en las zonas rurales es fundamental para impulsar el desarrollo agrícola y regional” (Bragachini et al. 2015).
Con el fin de mitigar los efectos negativos que se producen en el medioambiente y de diversificar la matriz energética nacional hacia fuentes de energías renovables, en Argentina se ha comenzado a delinear desde el año 2001 diversos mecanismos de promoción de la bioenergía, entre los que se encuentra la generación de energía en base a biomasa a partir del tratamiento de residuos provenientes de la producción agropecuaria y agroindustrial. Sin
1 La biomasa es la materia orgánica, ya sea de origen animal o vegetal, la cual incluye a su vez los residuos provenientes de su transformación natural o artificial.
174 DESARROLLO SOSTENIBLE
embargo, los primeros impulsos estaban orientados específicamente a la producción de biodiesel y bioetanol (Decreto 1396/2001, Resolución 1156/2004). Recién en el año 2006 se incluyó al biogás en los marcos de promoción de los biocombustibles a través de la Ley 26.093 del Régimen de Regulación y Promoción para la Producción y Uso Sustentables de Biocombustibles, reglamentada en el año 2007 por el Decreto 109/2007 (Flexor et al. 2012). La ley establece que la Secretaría de Energía, (actualmente denominada Ministerio de Energía y Minería), será la Autoridad de Aplicación. Además, dicho organismo tendrá la facultad de fijar las normas de calidad y seguridad, de establecer y llevar un registro de productores y comercializadores y de aprobar proyectos que puedan ser favorecidos por el régimen promocional.
El INTA posiciona a la bioenergía dentro de su agenda de trabajo a través de sus Programas Nacionales. Desde varias décadas atrás este organismo viene desarrollando estudios vinculados a temas bioenergéticos, los cuales se desarrollaron en torno a la gestión de los residuos animales para poder obtener biogás. Así, surgen el Programa Nacional de Bioenergía y la Red de Cooperación de Políticas Públicas Agropecuarias, ambos abocados al estudio de las políticas públicas en agroenergía, que contribuyen al equilibrio medioambiental y a la mitigación de la pobreza. El programa apunta a impulsar emprendimientos que puedan asegurar un suministro energético basado en fuentes renovables, de modo de incrementar la participación de la bioenergía dentro de la matriz energética nacional. El programa se vincula con diversos organismos, ya sean nacionales o del exterior, lo cual contribuye a abordar de modo más eficiente los temas vinculados a la demanda energética (Hilbert et al. 2011).
Otros programas fueron implementándose a los largo de estos años. Sin embargo, cabe destacar uno de ellos, vigente en la actualidad. En Julio de 2016, el gobierno nacional lanza el programa RenovAr Ronda 1, que contempla la producción de bioenergía (sobre la base de la biomasa) a partir del biogás obtenido en reactores anaeróbicos ó biodigestores. En Octubre de 2017, lanza el RenovAr Ronda 2 y en Noviembre de 2018, el RenovAr Ronda 3, todos ellos provenientes del Ministerio de Energía y Minería. Las perspectivas en cuanto a la generación de energía sobre la base de la biomasa son muy alentadoras. Según el Ministerio de Energía y Minería (2017) la cantidad de proyectos presentados en la Ronda 2 superaron ampliamente a los de la Ronda 1, distribuyéndose en su mayoría entre las provincias de Buenos Aires, Santa Fe y Córdoba.
Paralelamente, el 24 de Enero de 2017 la provincia de Buenos Aires pone en marcha el Plan de Bioeconomía, el cual contempla, entre otros aspectos, la concreción de acuerdos vinculados a inversiones en energías renovables. El cambio de rumbo propuesto en la forma de producir implicó el involucramiento de las distintas cadenas productivas, asociaciones y empresas, en un marco en el que comenzó a ser posible producir en forma sustentable. Dentro de este contexto, fue importante contar con un marco institucional que posibilitó la articulación sobre un eje común a las diferentes organizaciones sobre las
175 REPENSANDO LOS TERRITORIOS
que se sustenta la actividad agropecuaria nacional, tales como el INTA, SENASA (Servicio Nacional de Sanidad y Calidad Agroalimentaria), CONICET (Consejo Nacional de Investigaciones Científicas y Técnicas), CIC (Comisión de Investigaciones Científicas), UUNN (Universidades Nacionales) y otras entidades vinculadas a la agroindustria. El objetivo central del mencionado plan tuvo que ver con la transformación de los residuos que generan impactos negativos al medio ambiente, y a partir de un adecuado tratamiento se contribuiría a paliar el déficit energético actual que tiene el país. También tuvo otros objetivos, tales como la producción de biocombustibles renovables y de alimentos funcionales, el desarrollo de biomateriales y la bio-remediación de suelos y aguas, el desarrollo de la industria genética, la identificación de cuencas bioenergéticas y la generación de un sistema provincial de información sobre bioeconomía. En relación al plan mencionado en el párrafo anterior, las áreas temáticas que están basadas en producciones agropecuarias sustentables e industrialización inteligente son las siguientes: 1- ovinos de carne y leche, 2- complejo forestal, 3- producción de colza, 4- piscicultura continental y de mar, 5- hortifruticultura y riego, entre otras. Las chacras experimentales ubicadas en los distintos puntos de la provincia de Buenos Aires, que totalizan unas 4800 hectáreas, estaban disponibles para realizar actividades que contemplaran la concreción de los diferentes ejes planteados en dichas áreas. Ello condujo a que se firmaran acuerdos para realizar ensayos con el propósito de producir syngas a partir del empleo de biomasa; en este proyecto participaron un establecimiento educativo y la Asociación Argentina de Productores de Siembra Directa (AAPRESID). Por otra parte, el Ministerio de Agroindustria de la Provincia de Buenos Aires ha firmado un convenio con un grupo empresario a los efectos de realizar ensayos tendientes a producir energía con el objetivo de reciclar los residuos de la agroindustria. Por otra parte, además de contar con el marco institucional, en Agosto de 2018 el Ministerio de Agroindustria de la provincia de Buenos Aires presenta el mapa del biogás, desarrollado por la Provincia de Buenos Aires para impulsar proyectos que sean potencialmente viables para producir biogás. Este mapa permite detectar qué zonas geográficas son estratégicas para generar energía renovable en función de la biomasa disponible geolocalizada a lo largo de toda la provincia.
Esta herramienta es impulsada por la Dirección provincial de Bioeconomía y Desarrollo Rural, y está dirigida a empresas privadas, organismos públicos y a todos aquellos inversores que tengan la iniciativa de desarrollar este tipo de proyectos. Esto posibilitará efectuar estudios de prefactibilidad, ya que en el mapa es posible visualizar la cantidad de biogás y electricidad que es posible producir a partir de residuos orgánicos provenientes de distintos tipos de actividades productivas.
176 DESARROLLO SOSTENIBLE
3. RENOVAR:
ADjUDICADOS
A continuación, se describirán algunos de los proyectos que fueron adjudicados en el marco del Programa RenovAr:
Villarino (Buenos Aires): En la localidad de Villarino, Partido de Patagones (ubicado en el sur de la provincia de Buenos Aires), se invertirán US$3 millones para producir biogás. De las 31 plantas de biogás adjudicadas en la segunda ronda del programa Renovar, esta es la única que está fuera de la zona núcleo del país. Con una inversión de US$3 millones producirá 1,2 Megavatios en base a residuos orgánicos de industrias instaladas en la zona, ya que en la región hay industrias cerealeras, papeleras, un frigorífico de pescado y otro de carne y un criadero de pollos, además de contar con los residuos generados en el sector hortícola, fundamentalmente aquel vinculado a la producción de cebolla.
Rojas (Buenos Aires): En la ciudad de Rojas avanza el proyecto para la instalación de una planta de biomasa. Con una inversión de US$ 45 millones, generará energía con los subproductos de la industria semillera y la proveniente de los municipios y comunas, derivada de la poda de árboles.
Santa Fe: La empresa Tanoni Hnos, de Santa Fe, dedicada a la elaboración de aceites vegetales, pondrá en marcha el proyecto Central Bombal Biogás. El mismo generará energía eléctrica a partir de diferentes residuos orgánicos, tales como estiércol animal, restos de la industria de aceites, restos de frutas, verduras y podas, subproductos agroindustriales y lodos y restos animales.
Gobernador Virasoro (Corrientes): En esta localidad se está proyectando la construcción de una planta eléctrica que generará energía renovable a partir de biomasa forestal. La central será inaugurada a mediados de 2019, y la misma producirá 40 MW de energía “limpia”. La obra significó una inversión de 60 millones de dólares por parte del grupo FRESA (Fuentes Renovables de Energía S.A), y el proyecto generó 200 empleos directos para la realización de la obra y el montaje electro-mecánico. También participaron 500 personas de todo el país como proveedores. El aserrín, las cortezas de pino y otros residuos biodegradables son considerados biomasa forestal. Son una fuente de energía renovable basada en la utilización de la materia orgánica que sirve como fuente de energía limpia. El hecho de utilizar desechos forestales para la generación de energía eléctrica evita la quema al aire libre, que puede generar problemas de contaminación por emisión de gases tóxicos. También evitará la acumulación en basurales, que produce metano, cuyo potencial de efecto invernadero es 21 veces superior al del dióxido de carbono.
Capitán Sarmiento (Buenos Aires): En esta localidad se emprenderá un proyecto que utilizará como insumo principal biomasa de origen vegetal y animal, aprovechando como combustible la “cama de pollo”, un residuo formado por cáscara de arroz con excremento de pollo, proveniente de los criaderos industrializados de aves de corral, de Granja Tres Arroyos. Se generará 7,2 MW.
177 REPENSANDO LOS TERRITORIOS
PROyECTOS
Las junturas (Córdoba): En la ciudad de Las Junturas fue adjudicado el proyecto de generación eléctrica en base a biomasa de cáscara de maní, con una potencia de 700 KW, basado en una innovadora tecnología de gasificación y purificación por vía seca.La empresa que llevará adelante el proyecto cuenta con amplia experiencia en la industria del gas y el petróleo, y levantará una planta de 0,5 megavatios de potencia que se generará en base al procesamiento de unas 9.000 toneladas de cáscara del maní al año.
Córdoba y Santa Fe: Los proyectos CT James Craik, CT San Francisco, ambos de Córdoba, CT Recreo y CT Bella Italia -ubicados en Santa Fe-, pertenecen a la empresa Universum Invenio Limited, y generarán energía eléctrica utilizando como insumos la gallinaza (estiércol de la cría de pollo), los purines (estiércol de cría de animales), restos de aceites de origen vegetal y animal, restos de frutas, verduras y poda, subproductos agroindustriales, lodos urbanos y agroindustriales, sustratos de origen animal sin procesar y cadáveres animales.
Río Salí (Tucumán): La empresa Alcovil S.A. formalizó el proyecto de biogás CT Citrusvil de 3 MW, en Banda del Río Salí, Tucumán, que utilizará como insumo los residuos del proceso de cosecha y producción de productos a base de limón. El otro proyecto de biogás es CT Citrusvil, propiedad de la empresa Alcovil S.A., ubicado en Tucumán, y utilizará como insumo los residuos del proceso de cosecha y producción de productos a base de limón.
Christophersen (Santa Fe): La planta de biogás “San Pedro Verde” genera electricidad de biogás a partir de efluentes de un tambo. Este proyecto, perteneciente a Adecoagro, de 1,42 MW de potencia instalada, fue el quinto adjudicado en la Ronda 1 del Programa RenovAr. La central eléctrica se encuentra ubicada en la localidad santafesina de Christophersen. La planta, ubicada a unos 370 Km. al sur de la provincia de Santa Fe, tuvo una inversión de 6 millones de dólares. Generó 160 puestos de trabajo directos y 600 indirectos en toda la zona de influencia. San Pedro Verde aprovecha los residuos orgánicos para la generación de energía de un tambo que funciona desde hace más de 10 años. Es una de las posibilidades que el sector tiene para hacer más eficiente y rentable su negocio. Este tipo de proyectos, además de la generación de energía a partir de fuentes renovables, implica un uso eficiente de efluentes, control de bacterias y vectores, y reducción de gases de efecto invernadero. juan Lerena (San Luis):En esta localidad se encuentra emplazado el Establecimiento Yanquetruz. Es una planta que produce biogás, construida con tecnología alemana, y procesa efluentes de cerdos y forraje de maíz. Esta planta de cogeneración genera 1,5 MW y sustituye el 100% de la energía térmica del criadero. Es una de las primeras plantas con tecnología alemana construida en el país, con una inversión cercana a los 4,7 millones de dólares. Cuenta con cuatro biodigestores (2 primarios y 2 secundarios) con capacidad de almacenamiento para 3000 metros cúbicos. El Establecimiento Yanquetruz es el resultado de un proyecto desarrollado por ACA - Asociación de Cooperativas
178 DESARROLLO SOSTENIBLE
Argentinas-. ACA es una cooperativa de cooperativas fundada el 16 de febrero de 1922; reúne a 160 cooperativas con 50.000 productores de las provincias de Buenos Aires, Santa Fe, Córdoba, Entre Ríos y La Pampa. El mismo está ubicado en la Ruta Provincial Nº 2 km 51 de la Provincia de San Luis.
El proyecto cuenta con una población de 1.300 cerdas madres y 18.500 cerdos, y el total de la energía generada a partir del purín se utiliza para autoabastecer el establecimiento completo. Una vez terminadas todas las etapas del proyecto, además de purín de cerdos, se procesará en los biodigestores silaje de maíz y/o sorgo y el total de energía generada será suficiente para autoabastecer su demanda de electricidad y entregar el resto al Sistema Integrado Nacional. Dicho volumen de energía equivale a los consumos de los puertos de la A.C.A. (entre ellos, dos de los más importantes del país: San Lorenzo y Quequén). Así, es posible afirmar que ACA produce gran parte de sus productos con energía limpia.
CONSIDErACIONES FINALES
La dinámica productiva evidenciada en las últimas décadas, dada fundamentalmente por los procesos de globalización de la economía y el vertiginoso avance tecnológico, han puesto en riesgo la calidad medioambiental. Esto ha conllevado a repensar a los territorios, configurando en ellos nuevas formas de producción con la finalidad de dar tratamiento a los desechos generados por las distintas actividades productivas.
Desde el sector público se han propuesto diversos mecanismos para disminuir los impactos ambientales negativos provocados por éstas. De este modo, en Argentina se comenzaron a diseñar marcos institucionales propicios tendientes a mitigar los efectos negativos que impactan en el medioambiente por medio de programas que incentivan la generación de bioenergía a partir de la biomasa.
REFERENCIAS BIBLIOGRÁFICAS
Bragachini M et al. (2015) Oportunidades de la bioenergía en el sector agropecuario: efluentes y cultivos energéticos, 5p. http://inta.gob.ar/ documentos/oportunidades-de-la-bioenergia-en-el-sector-agropecuario-efluentes-y-cultivos-energeticos. Acceso febrero de 2016. Conesa Fernández V (1993) Guía metodológica para la evaluación del impacto ambiental. Ed. Mundi-Prensa. Madrid. España, 864p. De la Maza CL (2007) Evaluación de impactos ambientales. En: Manejo y conservación de recursos forestales. Editorial Universitaria, pp.579-609. Di Paola M (2013) La producción de biocombustibles en Argentina. http:// www.google.com.ar/#q=la+produccion+de+biocombustibles+en+argentina. Acceso febrero de 2016.
179 REPENSANDO LOS TERRITORIOS
Elías Castells X (2012) Tratamiento y valorización energética de residuos. Ediciones Díaz de Santos, SA. Madrid, 1256p.
Flexor G, Kato M, Recalde M (2012) “Mercado de Biodiesel y las políticas públicas: Los casos de Argentina y Brasil en forma comparada”, en Revista de la CEPAL, 108:71-89.
Hilbert A et al. (2011) Programa Nacional del INTA PNB 2011. http://inta.gob. ar/documentos/programa-nacional-de-bioenergia-del-inta-pnb. Acceso febrero de 2016.
INTA (2007) Enfoque de Desarrollo Territorial Rural. Programa Nacional de Apoyo a los Territorios. Ediciones INTA, pp.1-20.
Ley Nº 26093: Régimen de Regulación y Promoción para la Producción y Uso Sustentables de Biocombustibles. Autoridad de aplicación. Funciones. Comisión Nacional Asesora. Habilitación de plantas productoras. Mezclado de Biocombustibles con Combustibles Fósiles. Sujetos beneficiarios del Régimen Promocional. Infracciones y sanciones. http://infoleg.mecon.gov.ar/ infolegInternet/anexos/115000-119999/116299/norma.htm. Acceso febrero de 2016.
Manzanal M, Arqueros M, Nussbaumer B (2007) Territorios en construcción. Actores, tramas y gobiernos: entre la cooperación y el conflicto. Edit. CICCUS. Buenos Aires, 40p.
Ministerio de Energía y Minería. Subsecretaría de energías renovables. https:// www.minem.gob.ar/www/833/25897/proyectos-adjudicados. Acceso febrero de 2016.
Schejtman A, Berdegué J (2004) Desarrollo territorial rural. División América Latina y el Caribe del Fondo Internacional de Desarrollo Agrícola y el Departamento de Desarrollo Sustentable del Banco Interamericano de Desarrollo. Centro Latinoamericano para el Desarrollo Rural, 1:7-46.
Shejtman A, Berdegué J (2006). Desarrollo territorial rural. En: Territorios Rurales, Movimientos Sociales y Desarrollo Territorial Rural. RIMISP. Centro Latinoamericano para el Desarrollo Rural, 54p.
180 DESARROLLO SOSTENIBLE
11
PAISA jES PRODUCTIVOS
Ana Ruth Meehan1 , Alicia Elena Bobone1 , María Virginia Piñero2 , Isabel Alejandra Francia1
1 Universidad Nacional de Córdoba (UNC), Facultad de Ciencias Agropecuarias, Cátedra de Espacios Verdes. Ing. Agr. Félix A. Marrone 746, (5001) Córdoba, Argentina. E- mail: anmeehan@ agro.unc.edu.ar
2 Universidad Nacional de Córdoba (UNC), Facultad de Ciencias Agropecuarias, Cátedra de Espacios Verdes y Facultad de Arquitectura Urbanismo y Diseño, Cátedra de Arquitectura Paisajista, Av. Haya de la Torre s/n, (5001) Córdoba, Argentina. E-mail: mvpinhero@agro.unc.edu.ar
INTRODUCCIÓN
Actualmente la falta de planificación territorial que existe en las ciudades latinoamericanas exige a los profesionales y responsables de la gestión a buscar nuevas soluciones. Mientras que en los ámbitos académicos se generan nuevas líneas de pensamiento y acción al respecto, en la sociedad se despierta el reclamo a derechos básicos como el acceso al alimento sano, trabajo digno, calidad de vida, calidad ambiental, etc. Hechos que se constituyen sin duda en motor de cambio de realidades locales y globales.
Se propone reflexionar y repensar la valoración de los paisajes productivos ligados a la alimentación saludable, en las nuevas concepciones del paisaje como concepto general y del paisaje productivo en particular. El desafío es recuperar el valor social, económico y ambiental de los paisajes productivos, como construcción de identidades locales y fuente de recursos para una mejor calidad de vida de la población.
1. CONCEPTO DE PAISA jE
El paisaje es abordado por diferentes disciplinas, cada una desde su enfoque, sin existir alguna que lo tome como su objeto de estudio central. Si bien no hay una epistemología única, frente a una misma realidad, estas diferentes visiones en muchos casos resultan complementarias. Se pueden agrupar a las distintas posturas que estudian el paisaje en dos grandes grupos, aquellas que lo hacen centradas en la estética del paisaje y las que lo abordan como objeto material en relación al territorio (Cruz Pérez y Español Echániz 2009).
Existen tantas formas de definir al paisaje como miradas del ser humano sobre su entorno. Cada mirada está guiada por las experiencias, la memoria, la formación y las expectativas de cada individuo o sociedad (Fig. 1A). En la Stadnik MJ, Velho AC, Zorrilla SE (eds.) Desarrollo Sostenible en la Producción Agroalimentaria
181
sociedad prevalece la mirada estética del paisaje; tal vez sea esta la razón por la que no se logra una conexión con los paisajes cotidianos. Se espera encontrar escenas bellas y no aquel entorno en el que se vive. El paisaje no es la imagen estática grabada en la foto, en la pintura, en el dibujo; es un fenómeno en constante cambio, con sus propias reglas, en relación al equilibrio necesario de los ecosistemas. Esta falta de conexión ocurre en todos los niveles, no se percibe el paisaje integral al estudiarlo por partes (el suelo, el agua, las plantas, los animales); el ser humano es parte pero no lo asume, vive en un rompecabezas. Gran parte de la sociedad no logra comprender la unidad que forman la naturaleza y el ser humano. Desde la antigüedad, los pueblos se conciben en el paisaje como una integridad. Estos pueblos no consideran a la tierra como un simple medio de producción, sino el ser que le da la vida y al cual hay que retribuir, incluso la llaman Madre, Pachamama, Territorio Ancestral. Sin embargo, consideran al territorio como el espacio donde se desarrolla diferentes actividades culturales, sociales, económicas y sagradas, entendiéndolo como un bien de propiedad y responsabilidad colectiva (Agredo Cardona 2006). Desde esta perspectiva, el vínculo que se genera entre el ser humano y el territorio es de tipo circular y de correspondencia, algo vivo y con historia, donde cada uno de los seres de la Madre Tierra tiene derechos específicos a su condición y apropiados para su rol y función dentro de las comunidades en los cuales existen (Fig. 1B) (Parlamento Latinoamericano 2011).

Figura 1. A) Interacción Ser Humano/Naturaleza; B) Relación cíclica Ser Humano/Naturaleza.
En base a esta concepción holística del paisaje y lo proclamado por el Convenio Europeo del Paisaje (2000), quienes retoman el concepto de paisaje como un bien colectivo, perceptual, dotado de carácter natural y cultural. La Red Argentina del Paisaje (2009) y la Iniciativa Latinoamericana del Paisaje (2017), lo entienden como el espacio donde el hombre vive y se relaciona con la naturaleza, en forma individual o colectiva, modificándola a partir de aspectos sociales, culturales, económicos, históricos y políticos.
182 DESARROLLO SOSTENIBLE
El paisaje trasciende lo netamente natural y no es patrimonio de quienes lo intervienen individualmente, es una creación y un bien social (Red Argentina del Paisaje 2009).
El paisaje entendido como recurso natural tiene una connotación económica, que no puede ser desconocida. Es por ello, que su uso en este sentido, debe ser planificado responsablemente para no agotarlo. Una sociedad que valora y defiende al paisaje, fortalece la protección del ambiente, garantizando así una mejor calidad de vida.
Según La Red Argentina del Paisaje (2009) la calidad del paisaje es un factor ambiental determinante para el sostén de la vida humana, relacionado esto con los bienes y servicios que los ecosistemas brindan. Así, el paisaje, es fuente de alimentos, agua, minerales, suelos, maderas, fibras, etc. y presta servicios de:
• Aprovisionamiento de los bienes en sí;
• Regulación: climática, del agua, de los residuos, de la propagación de enfermedades;
• Valores culturales: belleza, inspiración, recreación;
• Servicios esenciales: fotosíntesis, formación de suelo, ciclado de nutrientes, diversidad biológica.
El paisaje es complejo en función de los sistemas que lo componen, desde sus elementos naturales, sociales, culturales y perceptuales. Además, es dinámico al estar en constante evolución. Estas características permiten clasificarlo según diferentes enfoques de abordajes.
Entonces, se puede hablar de paisajes urbanos, rurales, culturales, sonoros, sociales, productivos, entre otros. Por lo tanto, el abordaje del paisaje requiere de una mirada y tratamiento interdisciplinario, tanto en ámbitos académicos como de gestión y producción.
2. EL PAISA jE PRODUCTIVO
Según las Leyes de Indias de España (1681), en los modelos de urbanización de las ciudades coloniales se reservaba un área de aprovechamiento de recursos naturales, materiales de construcción, energía, alimentos y agua, siendo las tierras de dominio público (Boccolini y Giobellina 2018). Con el paso del tiempo, gran parte de esas tierras se comercializaron y fueron utilizadas con otros fines. Así, el crecimiento de las manchas urbanas superó las barreras naturales y las ciudades se extendieron sin una planificación adecuada.
Los espacios que antiguamente se utilizaban para la provisión de alimentos fueron devorados por intereses urbanísticos y de inversiones inmobiliarias, privilegiando las ganancias privadas y la concepción errónea de progreso. Esta situación se repite en diferentes ciudades y tiene un pulso en el tiempo donde surgen nuevas estrategias y planificaciones, que incluyen tierras desti-
183 PAISAJES PRODUCTIVOS
nadas al sustento de la población y que nuevamente los intereses económicos y privados ganan la pulseada generando pérdidas para la comunidad respecto a la calidad alimenticia, costos, distancias y identidad cultural (Fig. 2).

2. Pulsos de valoración del paisaje productivo.
Es imperiosa la necesidad de revalorizar como bien tangible e intangible el paisaje productivo, la relación que establece el ser humano con la tierra a través del trabajo y a partir de allí que el proceso de la producción de alimentos sea justo social y económicamente (Fig. 3).

FUENTE DE rECurSO PArA LA POBLACIÓN
• Trabajo y alimento saludable


• Turismo productivo


OPORTUNIDAD DE INTERCAMBIO SOCIAL
• Producción y comercialización


• Construcción de identidades territoriales
• Agroecología
SErVICIOS AMBIENTALES


• Uso eficiente del agua, la energía y el suelo
Figura 3. Revalorización del paisaje productivo.
El valor productivo del paisaje es la capacidad que el mismo tiene para proporcionar beneficios económicos, convirtiendo sus elementos en recursos
184 DESARROLLO SOSTENIBLE
Figura
que aporten al desarrollo sostenible y sustentable, tales como la agricultura y la ganadería profundizando sus rasgos patrimoniales (Red Argentina del Paisaje 2016). Los paisajes productivos, en sus diferentes escalas, aportan a ocho Objetivos de Desarrollo Sostenible.
Los paisajes productivos, a nivel regional son fuente de recurso para los pobladores, se constituyen en un atractivo turístico y son base de las economías regionales. De esta manera, a nivel local es un motor para el desarrollo, un medio para incrementar la paz, la identidad, la economía y la calidad de vida de la comunidad (FAO 2015, Red Argentina del Paisaje 2016).
El paisaje productivo se constituye en una oportunidad para revertir desequilibrios en los sistemas ambientales, sociales, económicos y tecnológicos en todas las escalas posibles de intervención (Fig. 4).

Según los espacios de abordaje se establecen rasgos distintivos: paisajes productivos en entornos urbanos degradados que incluyen un abanico de campos de acción asociados al sistema de áreas verdes de la ciudad, incluyendo espacios de dominio público y dominio privado. Paisajes productivos en espacio periurbanos degradados, amenazados con el avance del tejido urbano y la producción agrícola e industrial contaminante, se presentan como oportunidades de nuevos equilibrios que garanticen equidad en el acceso al alimento sano, fuelle y freno para las actividades contaminantes y regeneración de economías locales.
185 PAISAJES PRODUCTIVOS
Figura 4. Paisajes productivos en el engranaje de la sostenibilidad.
2.1 Paisajes productivos regionales: San Marcos Sierras, el pueblo de la miel Los productores de la zona de San Marcos Sierras (provincia de Córdoba), conscientes de la importancia del monte nativo, se organizaron en su defensa y preservación, realizando acciones concretas tales como la conformación de la Mesa Apícola del Noroeste, la obtención de la indicación geográfica y la denominación de origen de “mieles de monte nativo del noroeste de Córdoba”, la realización de talleres participativos de ordenamiento territorial y actividades de promoción y difusión de la miel de San Marcos Sierras. También constituyeron cooperativas apícolas, lograron financiamiento para maquinaria e insumos y acompañamiento técnico y pudieron acceder a subsidios para mejorar la infraestructura de las salas de extracción y la adquisición de equipamiento para aumentar la producción (Barreda et al. 2017). La miel allí producida, tiene al más alto contenido polínico del centro de Argentina, lo que le da una alta capacidad nutritiva y terapéutica, al igual que los subproductos polen y propóleo que de ésta se obtienen (Barreda et al. 2017). Esta miel se caracteriza con su sello de origen y constituyéndose también el paisaje donde es producida en un atractivo turístico (Córdoba Turismo 2017).
2.2 Agricultura urbana y agroecología como estrategias de intervención del paisaje productivo En entornos rurales o en las periferias de la mancha urbana, el avance de la urbanización que desconoce riesgos de rupturas en los sistemas ambientales, la contaminación permanente y la aplicación descontrolada de agroquímicos en suelos productivos, el monocultivo y la falta de políticas que defiendan a los pequeños productores amenazan constantemente la calidad de vida de sus habitantes. El crecimiento de la población también trae como consecuencia el crecimiento de la demanda de alimento saludable.
Ante este panorama, surge la necesidad imperiosa de reinterpretar y repensar otras formas de intervenir y gestionar el paisaje. Es por ello, que el paisaje debe enfocarse desde una mirada plural e interdisciplinaria que incluya al arte, literatura, agricultura, ecológica, arquitectura, economía, etc. (Red Argentina del Paisaje 2016).
Según Altieri (2019), 80% de la población mundial vivirá en ciudades, incluyendo el 56 y el 20% de los más pobres y malnutridos, respectivamente. El autor estima que para alimentar una ciudad de 10 millones de habitantes se deben importar diariamente 6 mil toneladas de alimentos, contemplando un transporte promedio de 1500 km. Este modelo agroindustrial no garantiza la provisión de alimentos a las grandes ciudades, ni que su precio sea accesible ante imprevistos.
Actualmente la producción de alimentos con el objetivo de mejorar la seguridad alimentaria, ha cobrado, una gran relevancia a nivel mundial y se presenta como una estrategia para resolver los conflictos asociados al modelo productivo imperante.
186 DESARROLLO SOSTENIBLE
La Seguridad Alimentaria se entiende como el acceso, tanto físico como económico, de todas las personas, en todo momento, a suficientes alimentos inocuos y nutritivos para satisfacer sus necesidades alimenticias y sus preferencias, a fin de llevar una vida activa y sana. Sin embargo, este concepto ha sido cuestionado por carecer de una posición política y por ser acrítico del sistema agroalimentario y las formas de producción (Giobellina 2015).
En la Cumbre Mundial sobre la Alimentación de 1996 la Vía Campesina lanzó el concepto de Soberanía Alimentaria donde expresa “el derecho de los pueblos a acceder a alimentos nutritivos y culturalmente adecuados, a definir sus propias políticas de producción sustentables y ecológicas, transformación, comercialización, distribución y consumo de alimentos, de modo tal que se garantice el derecho a la alimentación de toda la población” (Giobellina 2015).
Los conceptos de Seguridad Alimentaria y Soberanía Alimentaria no deben considerarse como antagónicos o alternativos.
La agricultura urbana comprende la producción de alimentos de origen vegetal y animal, fibras, cultivos florales, plantas medicinales, tintóreas, etc., a escala familiar y comunitaria prescindiendo del uso de agroquímicos. Resulta en una actividad sustentable al utilizar con fines productivos recursos insuficientemente utilizados tales como terrenos baldíos, aguas residuales tratadas, mano de obra desempleada y residuos reciclados (Moreno Flores 2007, Schonwald y Pescio 2015).
La agricultura insumo dependiente rompe la relación del ser humano con los procesos productivos naturales. En tanto que, la Agroecología surge como paradigma de producción sustentable, ofreciendo oportunidades laborales, alimentos sanos, equidad social y restableciendo el vínculo del ser humano con la tierra y su identidad (Fig. 5) (Giobellina 2015).
3. IMPORTANCIA DE LOS CINTURONES VERDES PERIURBANOS
Las zonas periurbanas no poseen límites precisos, en ellas se entremezclan las áreas urbana y rural, y se combinan los usos del suelo y las formas de vida del campo y la ciudad. En estas zonas se producen los cambios morfológicos, funcionales y de población más rápidos y profundos de todo el espacio urbano (Zamorano 1992, Zárate Martín 1996).
Los cinturones verdes aportan a las ciudades una fortaleza estratégica para garantizar la provisión de alimentos frescos y con una pequeña huella de carbono; también son importantes los diferentes aportes ecológicos y económicos que generan, siendo intangibles de gran valor y sin estar contabilizados en los presupuestos públicos.
Entre los servicios que prestan los cinturones verdes hortícolas periurbanos se destacan: alimentos a costo 0 km, integración del campo y la ciudad, generación de empleo local, límite al crecimiento urbano, alimentos saludables disponibles en cantidad y calidad, seguridad y soberanía alimentaria, resi-
187 PAISAJES PRODUCTIVOS
liencia y adaptación de los cultivos, valorización de los productos hortícolas y precios justos para productores y consumidores. También es muy importante el aporte de los trabajadores rurales en cuanto a mantener sus técnicas de cultivo, mejorando el suelo, los sistemas de riego y la evolución de la agricultura familiar (Giobellina 2017, Tittonell y Giobellina 2018).

SOBErANIA ALIMENTARIA





OPTIMIZACIÓN DE LOS RECURSOS: ÁGUA, ENERGIA Y SuELO


ALIMENTOS SALuDABLES

AGrOECOLOGÍA



DESArOLLO DE ECONOMÍAS LOCALES




jARDINES COMESTIBLES (PÚBLICOS Y PrIVADOS)


IDENTIDAD CULTURAL


TURISMO PRODUCTIVO

Figura 5. Aportes de la agroecología a la sustentabilidad.
Las agriculturas familiares en el periurbano tienen la característica particular de reconocer el valor del saber científico, conservan el conocimiento de las técnicas que tradicionalmente se han utilizado, en las que el respeto por los recursos naturales y la concepción holística de la producción no son considerados mercancías, sino alimentos; el hombre y la familia son partes del todo (Giobellina 2017, Tittonell y Giobellina 2018).
Con el fin de sostener estos emprendimientos es necesario intensificar el trabajo territorial y social de las diferentes entidades, comprometiendo una mayor participación de la comunidad en las decisiones sobre el uso del suelo frente al avance inmobiliario. Esto es importante sobre todo en los cinturones verdes de las ciudades medianas y grandes para promover la puesta en marcha de procesos de transición agroecológica (Tittonell y Giobellina 2018).
188
DESARROLLO SOSTENIBLE
Aplicar la Agroecología en espacios periurbanos contribuirá a generar una acción social colectiva, con sistemas de control participativos y democráticos. La transición hacia la Agroecología es el paso del “modelo agroquímico” a estilos de producción más evolucionados desde el punto de vista de la conservación de los recursos naturales, en donde el proceso social está orientado a la obtención de índices más equilibrados de resiliencia, productividad, estabilidad y equidad en la actividad agropecuaria (Tittonell y Giobellina 2018).
4. FERIA AGROECOLÓGICA DE CÓRDOBA
La Feria Agroecológica de Córdoba surgió como una iniciativa de diversos sectores preocupados por la alimentación de los ciudadanos. Se reunieron, para ello, distintas instituciones: INTA Pro Huerta, la Secretaría de Agricultura Familiar y la Universidad Nacional de Córdoba (UNC) y formaron la Mesa de Agricultura Urbana con el objetivo de promover espacios de investigación e intervención acerca de la producción de alimentos saludables, libres de agrotóxicos y sin aditivos que pudieran ser nocivos para la salud. Se presentó un proyecto de extensión universitaria, y a partir del mismo, la feria comenzó a realizarse en un predio de la Ciudad Universitaria (Hernández 2017).
La feria cuenta con el apoyo de instituciones públicas nacionales, provinciales y municipales, mientras que los productores son asesorados y provistos de semillas por el Programa Pro Huerta del INTA y por el Ministerio de Desarrollo Social de la Nación.
La Feria Agroecológica de Córdoba reúne a productores familiares organizados para comercializar sus productos con consumidores que buscan alimentos de calidad y a un precio justo. La primera feria se realizó en noviembre de 2013, en la plaza seca de la UNC. Al principio las reuniones eran quincenales, pero debido a la demanda hace tiempo que los encuentros se realizan semanalmente, en el mismo lugar. Al comienzo la Cooperativa San Carlos y productores para autoconsumo aportaban sus producciones; en la actualidad, la oferta se ha ampliado, incrementando el número de productores, la calidad y cantidad de productos. Debido a la buena respuesta generada en esta feria, se ha generado un efecto multiplicador y otros espacios vecinales se han sumado a la iniciativa. Por lo tanto, esta actividad tiene un papel importante como motor de cambio de la realidad local.
5. AGRICULTURA URBANA EN ESPACIOS VERDES PÚBLICOS y PRIVADOS
El diseño de las áreas verdes públicas y privadas no es ajeno al nuevo paradigma de paisajes productivos. Así es que se dejan de pensar puramente desde la estética, concebida como un lujo, adquiriendo nuevos roles y funciones que resultan en jardines educativos, terapéuticos, comestibles, etc.
189 PAISAJES PRODUCTIVOS
Los bosques urbanos proveen alimentos (frutos, semillas, hojas), son fuente de forraje para la crianza de animales, garantizan el suministro de agua de buena calidad para beber y cocinar y proveen leña de fácil acceso y bajo costo, evitando la depredación de los bosques naturales; tienen el potencial de producir grandes cantidades de productos frescos y de bajo costo para la población local (FAO 2016).
6. PAISA jE PRODUCTIVO EN EL ÁMBITO EDUCATIVO
En 2015, en el marco de las actividades prácticas del Módulo Proyecto II de la carrera Tecnicatura Universitaria en Jardinería y Floricultura (TUJyF) de la Facultad de Ciencias Agropecuarias de la Universidad Nacional de Córdoba (FCA UNC), se propuso trabajar en el espacio público en torno a la cantina de la Facultad. Para ello, se realizó un análisis general y particular, consultas a los usuarios del espacio (docentes, estudiantes, no docentes) y una propuesta trabajada con metodología de diseño participativo guiado por los docentes del espacio curricular.
El desafío fue recrear un paisaje productivo a partir de la combinación de cereales, hortalizas y especies aromáticas que pudieran aprovecharse como insumo saludable en las comidas que elabora la cantina y para saborizar el mate. Esta última, es una infusión tradicional muy arraigada a nuestra ciudad y a los estudiantes en particular. El jardín se ejecutó dentro del año lectivo resultando en una experiencia enriquecedora y un disparador de nuevos paradigmas en la construcción de jardines públicos comestibles.
7. PAISA jE PRODUCTIVO EN EL ÁMBITO DE LOS ESPACIOS VERDES PÚBLICOS
Dentro de la propuesta paisajística del parque comunal de la comuna de Damián Maisonnave (provincia de La Pampa) se proyectó un jardín comestible en torno al sector de camping, destinando una superficie aproximada de 1 hectárea para tal fin. En la propuesta general se resolvió la delimitación de zonas de acampe a partir de la vegetación con especies aromáticas principalmente y frutales, que junto con las piezas duras construidas (asadores) configuran el sistema de subespacios de éste sector del parque (Piñero et al. 2019).
CONSIDErACIONES FINALES
La incorporación de paisajes productivos en las áreas urbanas y periurbanas bajo los principios de la agroecología es una oportunidad para recuperar áreas degradadas y lograr seguridad alimentaria de los habitantes. La creación de nuevas formas de trabajo y encuentro entre productores, técnicos, la socie-
190 DESARROLLO SOSTENIBLE
dad, las instituciones estatales y organismos no gubernamentales se presenta como un nuevo paradigma de la gestión del paisaje productivo. “En el ser humano la alimentación pone de manifiesto la indisoluble relación entre la biología y la cultura, nuestro organismo necesita de nutrientes para asegurar las funciones vitales. Incorporamos elementos del entorno que transformamos en un plato de comida y que el organismo procesa para obtener materia y energía. Sin embargo, cada cultura define sus preferencias y aversiones alimentarias y consume solo una parte de las sustancias disponibles, sabores, olores, formas y colores provocan nuestros sentidos modelando el gusto y el placer. El hecho alimentario es, ante todo, un acto social y forma parte de nuestros rituales cotidianos. Así, los alimentos se impregnan de significados, producen historias, promueven encuentros, movilizan recuerdos y refuerzan lazos de pertenencia” (Museo de Ciencias Naturales de La Plata).
REFERENCIAS BIBLIOGRÁFICAS
Agredo Cardona GA (2006) El territorio y su significado para los pueblos indígenas. Revista Luna Azul 23, pp.28-32.
Altieri MA (2019) ¿Puede la agricultura urbana alimentar a las ciudades? Leisa. Revista de Agroecología. http://www.leisa-al.org/web/index.php/lasnoticias/alimentacion-saludable/3683-puede-la-agricultura-urbana-alimentar -a-las-ciudades-2. Acceso Marzo 2019.
Barreda M et al. (2017) La flora nativa como el bien común de los apicultores del noroeste de Córdoba: desafíos para su gestión. Revista Idelcoop, 221:685.
Boccolini SM, Giobellina B (2018) Reconstrucción histórica del territorio periurbano de producción hortícola de Córdoba, Argentina (1573-1900). Eutopía: Revista de Desarrollo Económico Territorial, (14):83-110.
Convenio Europeo del Paisaje (2000) www.mapa.gob.es/es/desarrollo-rural/ planes-y-estrategias/desarrollo-territorial/090471228005d489_tcm30421583.pdf. Acceso Marzo 2019.
Córdoba Turismo (2017) San Marcos Sierras, “el pueblo de la miel”. https:// www.cordobaturismo.gov.ar/san-marcos-sierras-el-pueblo-de-la-miel.Acceso Abril 2019.
Cruz Pérez L, Español Echániz I (2009) El paisaje. De la percepción a la gestión. Editorial Liteam, Madrid, 259p.
FAO (2015) Objetivos de Desarrollo Sostenible. http://www.fao.org/sustainable-development-goals/es. Acceso Febrero 2019.
FAO (2016) Directrices para la silvicultura urbana y periurbana. Estudio FAO, Roma, 179p.
Giobellina B (2015) Observatorio O-AUPA en Córdoba: perspectivas de la agricultura urbana y periurbana en Córdoba. Ediciones INTA, Córdoba, 96p.
Giobellina B (2017) El cinturón verde de Córdoba: hacia un plan integral para la preservación recuperación y defensa del área periurbana de producción de alimentos. Ediciones INTA, Manfredi, 36p.
191 PAISAJES PRODUCTIVOS
Hernández M (2017) La feria agroecológica y sus cuatro años en el Bosquecito de la FCC. https://noqueremosinundarnos.blogspot.com/2017/10/la-feria -agroecologica-y-sus-cuatro.html. Acceso Abril 2019.
Iniciativa Latinoamericana del Paisaje (2017) Paisaje. http://www.lali-iniciativa.com. Acceso Marzo 2019.
Moreno Flores O (2007) Agricultura urbana: nuevas estrategias de integración social y recuperación ambiental en la ciudad. Revista Electrónica Diseño Urbano y Paisaje. http://repositorio.uchile.cl/bitstream/handle/2250/117766/ Articulo_agricultura_urbana%20%28revista%20DU%26P%29.pdf?sequence=1&isAllowed=y. Acceso Febrero 2019.
Parlamento Latinoamericano (2011) Declaración universal de los derechos de la Madre Tierra. XXVII Asamblea del Parlamento Latinoamericano. http:// parlatino.org/pdf/organos-principales/asamblea/declaraciones-resoluciones-actuales/pma-2-12-2011/declaraciones/declaracion10-universal-derechos-tierra.pdf. Acceso Marzo 2019.
Piñero MV, De Blas F, Sánchez S, Riachi P (2019) Proyecto paisajístico parque comunal Damián Maisonnave, La Pampa, República Argentina. https://congresoparques.com/salta/assets/material/Una%20Ciudad%20Jard%C3%ADn.pdf. Acceso Octubre 2019.
Red Argentina del Paisaje (2009) Glosario. http://www.redargentinadelpaisaje. com/index.php?b=r#glosario. Acceso de Marzo 2019.
Red Argentina del Paisaje (2016) Carta de Tucumán. VII Encuentro de la Red Argentina del Paisaje. http://www.redargentinadelpaisaje.com/index. php?b=r#tucuman. Acceso Marzo 2019.
Schonwald J, Pescio F (2015) Mi casa, mi huerta: técnicas de agricultura urbana. Ediciones INTA, Ciudad Autónoma de Buenos Aires, 66p.
Tittonell P, Giobellina B (2018) Periurbano hacia el consenso: ciudad, ambiente y producción de alimentos: propuestas para ordenar el territorio: resúmenes ampliados: libro 1. Ediciones INTA, Ciudad Autónoma de Buenos Aires, 757p.
Zamorano M (1992) Geografía urbana. Formas, funciones y dinámica de las ciudades. Ceyne, San Isidro, 139p.
Zárate Martín A (1996) El espacio interior de la ciudad. Síntesis, Madrid, 253p.
192 DESARROLLO SOSTENIBLE
12
QUESOS ARTESANALES ANCESTRALES y EL AGrEGADO DE VALOr
Olga Myriam Vasek1 & Natan de Jesus Pimentel-Filho2
1 Universidad Nacional del Nordeste (UNNE), Facultad de Ciencias Exactas y Naturales y Agrimensura, Instituto de Modelado e Innovación Tecnológica (CONICET). Avda. Libertad 5450, (3400) Corrientes, Argentina, E-Mail: omvasekk@yahoo.com.ar
2 Universidade Federal de São Carlos (UFSCar), Centro de Ciências da Natureza, Rod. Lauri Simões de Barros, km 12, SP-189, 18240-000, Buri-SP, Brasil. E-mail: npimentel@ufscar.br
INTRODUCCIÓN
La producción de alimentos en todo mundo encuentra soporte legal en las normativas establecidas por las Instituciones Gubernamentales. Estas normativas, favorecen a las grandes industrias que producen alimentos a gran escala y, por lo tanto, además de promover la homogeneidad de los productos entre lotes, presentan programas y directrices básicas para que se cumplan los requisitos mínimos de calidad higiénica con el objetivo de minimizar o extinguir los riesgos para la salud de los consumidores.
A su vez, las pequeñas agroindustrias, muchas veces familiares, buscan producir alimentos seguros desde el punto de vista de la Salud Pública, y al mismo tiempo diferenciados, aunque la mayoría de las veces, sin amparo legal. En este contexto, los alimentos artesanales, muchas veces llamados tradicionales o productos de la tierra, lograron destacarse. Éstos, al contrario de los elaborados por grandes industrias, presentan reducida homogeneidad entre procesos de producción debido a una serie de factores externos, especialmente ambientales, que influyen directamente en sus características sensoriales (Perondi et al. 2019, Santos 2014).
En los últimos años, el número de consumidores que buscan una alimentación más variada, saludable y nutricional, o productos mínimamente procesados, libres de aditivos como conservantes, colorantes, acidulantes, entre otros, creció exponencialmente. Atendiendo a esta demanda, los productores de alimentos ofrecen los llamados “productos gourmet”, alimentos diferenciados y con elevado valor agregado (Mozdzenski y Silva 2019).
Una gran variedad de alimentos se produce de manera artesanal, generalmente por familias que solventan su sustento con esta producción. Estos productos constituyen un patrimonio cultural y, a su vez, se presentan diferenciados y con valor agregado, posibilitando una intensa experiencia gustativa. Ejemplos de este tipo de alimentos son los embutidos cárneos, jaleas y comStadnik MJ, Velho AC, Zorrilla SE (eds.) Desarrollo Sostenible en la Producción Agroalimentaria
193
potas de frutas, conservas vegetales, salsas de tomate y pimienta, y quesos manufacturados a partir de leche cruda. Cada uno de ellos presenta una gran variabilidad en función de la región productiva y la calidad de la materia prima, entre otros.
La producción artesanal de quesos es una de las más antiguas y tradicionales actividades ligadas a los beneficios de la leche. Estos productos son objeto de investigaciones en diferentes áreas, en razón de su importancia nutricional, cultural y, principalmente, socio-económica para la agricultura familiar, pues aseguran ingresos y trabajo en el campo (Dallabrida et al. 2018). De forma general, el proceso de elaboración ocurre a pequeña escala y se realiza en la propiedad rural. Las características finales de los quesos son propias del terruño, y están vinculadas al clima, pasturas, prácticas de producción y microorganismos presentes en cada región. Más allá de eso, la producción de quesos artesanales puede ser considerada una actividad histórica y cultural una vez que el “modo de hacer” pasa de generación a generación. Si por un lado el queso artesanal está dotado de características exclusivas tornándose particular, por otro existen obstáculos para su comercialización frente a las restricciones legales para un producto elaborado a partir de leche cruda. Recientemente, y debido a la presión de diversos sectores de la sociedad, existe un esfuerzo gubernamental para que los quesos artesanales manufacturados a partir de leche cruda puedan comercializarse cumpliendo criterios mínimos de calidad que otorguen seguridad al consumidor.
Por otra parte y, de acuerdo con las proyecciones realizadas por la Organización para la Cooperación y el Desarrollo Económico y la Organización de las Naciones Unidas para la Alimentación y la Agricultura, la población urbana crecerá originando un desarraigo del terruño y la población rural disminuirá en todo el mundo provocando un incremento de las tareas no agrícolas, disminuyendo la producción de alimentos artesanales rurales. Si bien el proceso de urbanización es muy avanzado en gran parte de los países desarrollados, en los países en desarrollo sigue aumentando y se estima que, para antes del año 2021, este porcentaje crecerá aún más (OECD-FAO 2016, 2015).
En las últimas décadas, surgieron sistemas de producción localizados que fueron incrementando su impacto e importancia sobre el desarrollo de la economía geográfica y regional. Estos distritos, regiones innovativas, regiones de aprendizaje y sistemas regionales de innovación, introducen nuevas construcciones teóricas y empíricas entre los desarrollos industriales y éstas, generando los Sistemas Regionales de Innovación y los Procesos Colectivos vinculados al Origen (Vandecandelaere et al. 2010). Las organizaciones llegan a ser triunfadoras cuando se percatan de las grandes oportunidades e inventan las prácticas venideras, construyendo las capacidades que podrán aprovechar en el porvenir (Prahalad 2010).
En este sentido, el mayor potencial se está dirigiendo a los micro-consumidores y micro-productores, presentándose, como una mega-oportunidad
194 DESARROLLO SOSTENIBLE
al desarrollo inclusivo, modelo de negocio tendiente a involucrar a las personas de zonas rurales en la innovación colectiva, y como otra mega-oportunidad al desarrollo sustentable.
Existe una interesante conexión entre los intereses para la reducción de la pobreza mediante actividades comerciales y la necesidad de aprender nuevas capacidades para competir, desarrollando modelos de negocio eficientes en sectores de pobreza que generen valor para todos los actores, que intervengan en áreas donde falla el mercado y que permitan superar algunos de los círculos viciosos de pobreza que atrapan a esta población (Mutis y Ricart 2008). Los modelos de negocio en la Base de la Pirámide económica (BDP) tienen un gran potencial de aprendizaje y crecimiento debido a la magnitud de la población a la cual están dirigidos, que en 40 años crecerá exponencialmente y constituirá el mercado mayoritario de acuerdo con el Banco Interamericano de Desarrollo (Azevedo et al. 2015).
En este capítulo, se abordará el respeto a la diversidad de quesos artesanales elaborados con leche cruda en Brasil y el agregado de valor a un queso de la región norte de Argentina, respetando su tradición ancestral y su carácter artesanal, con posibilidades de insertarse comercialmente mediante un modelo de negocios en la BDP.
1. QUESOS ARTESANALES DE BRASIL
Brasil es un país continental descubierto por los europeos en el año 1500. Sus dimensiones territoriales, sus características de relieve, vegetación y clima son ampliamente variadas, así como su diversidad cultural; esto hace que el país presente características regionales bastante distintas.
En sus inicios, el país fue una colonia de exploración y su aumento poblacional ocurrió, básicamente, a lo largo de la costa marítima. Con el descubrimiento del oro en el estado de Minas Gerais, a fines del siglo XVIII, la región atrajo un gran número de personas interesadas en la explotación del metal precioso y del comercio local (Castro et al. 2012). Minas Gerais es un estado con relieve accidentado con muchos valles y montañas en su región central donde el oro fue hallado inicialmente y posteriormente, diamantes y otras piedras preciosas (Carrara 2000, Silva 1995). Con el aumento de la población regional, se trajeron vacas lecheras para suplir a la población con leche. Así nacieron las primeras granjas en el estado.
La producción de quesos surgió como alternativa para el aprovechamiento de la leche excedente o como forma de conservación cuando la leche no podía ser comercializada en función de las dificultades para su transporte desde las haciendas hasta los pueblos. Por lo tanto, basados en las técnicas utilizadas por los portugueses en la producción del queso Serra da Estrela, surgieron los primeros Quesos Minas Artesanales. Hoy, el estado posee siete regiones productoras de Queso Minas Artesanal: Araxá, Alto Paranaíba (Cerra-
195 QUESOS ARTESANALES
do), Campo das Vertentes, Canastra, Serra do Salitre, Serro y Triángulo Mineiro (IMA 2018; IPHAN 2014).
La producción de estos quesos, generalmente, emplea leche cruda, ordeñada en la propia granja que después de filtrada, recibe el agregado de cuajo y “pingo”, elemento fundamental para la diversidad del producto. El “pingo” es un fermento endógeno obtenido al final del proceso de desuerado de los quesos (Dores y Ferreira 2012). Está compuesto por una variedad de bacterias lácticas intrínsecas a cada región productora. Tal diversidad confiere características diferenciales a los quesos entre las regiones. Después de la coagulación, la masa se corta, desuera y se le da forma. La masa formada se prensa para liberar el suero y el modo de ejecución varía de región a región. En el Serro, se utilizan sólo las manos en el proceso mientras que en Canastra, Serra do Salitre y Alto Paranaíba, se emplean tejidos. El salado se realiza en la superficie de los quesos que luego se maduran por un período que varía de acuerdo con la región productora.
Además del Queso “Minas Artesanal”, el estado de Minas Gerais posee otros importantes quesos elaborados de manera artesanal. Vale destacar el Queso “Parmesão de Mantiqueira” producido en Serra de Mantiqueira, el “Parmesão de Alagoa” elaborado en el municipio de Alagoa y el “Requesón Moreno”, típico de la región norte del estado. El Queso “Cabacinha”, producido en el Valle de Jequitinhonha es otro producto apreciado, versión brasileña del queso italiano Caciocavallo, hecho con masa cocida en agua hirviendo, desuerada, hilada y moldeada en forma de una calabaza. Posteriormente, los quesos se atan a sus pares y se secan, pudiendo ahumarse o rellenarse con manteca (Santos Filho et al. 2017).
Aunque el estado de São Paulo no es conocido por la tradición de quesos artesanales, un tipo especial de queso conocido como Requesón de Prato (Requeijão de Prato) se produce artesanalmente en diversos municipios de la región Valle del Paraíba. Otro queso artesanal centenario, fabricado en granjas de la región sudoeste del estado es el Queso “Porungo”. El producto recibe este nombre en función de su forma semejante al fruto poronga (Lagenaria siceraria). Se fabrica a partir de leche cruda coagulada por la acción de cuajo comercial y fermentado por la adición de suero-fermento que contiene la microbiota característica naturalmente presente en la leche, lo cual confiere características sensoriales peculiares al producto. El queso “Porungo” posee características sensoriales bastante próximas a las del queso Mozzarella, considerándose un queso de elevada humedad y semi-graso a graso. Su corteza es generalmente blanquecina y la masa es blanca y consistente, pudiendo, a veces, ser ligeramente quebradiza. Este queso es conocido, también, como Cabacinha, Porunguinho, Nozinho, Cabecinha, Enforcado y Pescocinho. Su comercialización representa una gran importancia económica, pues es fuente de ingresos para numerosos pequeños productores que los venden directamente a los consumidores o en mercados de la región y ferias libres; quesos de igual
196 DESARROLLO SOSTENIBLE
nombre se producen en la región Campos Gerais del estado de Paraná. Dada la proximidad territorial de las regiones Campos Gerais (Paraná) y Sudoeste Paulista y Valle de Ribeira (São Paulo), el queso Porungo presenta características sensoriales y de producción muy semejantes en los dos estados (Santos 2017). La región sur de Brasil está compuesta por los estados de Paraná, Santa Catarina y Rio Grande do Sul, en ellos se produce una gran diversidad de quesos artesanales. El Queso “Colonial”, tradicional en los tres estados, se elabora a partir de leche cruda adicionada de muy poco cuajo y sal. Después de la coagulación, la masa desuerada se transfiere con auxilio de un tejido al molde y se somete a prensado manual. El queso se retira de la prensa al día siguiente y se madura. Su tiempo de maduración es variado, pudiendo ser de apenas 5 días o por un período superior a 30 días (Carvalho 2015, Bánkuti et al. 2017).
El Queso “Serrano” se elabora hace 200 años aproximadamente, en comunidades rurales de las regiones Serrana de Santa Catarina y Campos de Cima da Serra en Rio Grande do Sul. El queso se manufactura conforme a la tradición histórica y cultural de la zona, a partir de leche cruda entera obtenida en la granja de origen. La leche filtrada se adiciona de cuajo para formar la cuajada. Después del corte, se desuera, se forma la masa, se prensa y los quesos generados se destinan a maduración. El producto presenta consistencia firme, color y sabor propios, masa uniforme, libre de colorantes y conservantes, a veces con ojos generados por razones mecánicas (Pereira et al. 2014, Ries et al. 2012).
En Santa Catarina, además de la producción de quesos Colonial y Serrano, pequeños agricultores producen los quesos artesanales “Diamante” (Major Gercino), “Contestado” (Valle de Contestado), “Queijinho” y “Kochkäse” (Valle de Itajaí). El Kochkäse se elabora utilizando leche cruda en un proceso que demora aproximadamente 7 días y totalmente desprovisto de equipamientos tecnológicos (Sakr y Dallabrida 2015).
La región Nordeste brasilera es la principal productora de Queso Coalho, un queso de masa blanca, forma rectangular, sabor levemente ácido y salado. El producto, considerado patrimonio de la cultura nordestina, se produce tradicionalmente a partir de leche de vaca cruda coagulada por la adición de cuajo comercial en los estados de Alagoas, Bahia, Ceará, Paraíba, Pernambuco, Rio Grande do Norte y Sergipe. Los quesos presentan consistencia firme y se consumen crudos, asados, fritos, solos o como acompañamiento (Almeida et al. 2013, Menezes 2011). Entre las unidades productoras de este queso, es posible observar pequeñas diferencias en referencia al prensado que puede ser manual o mediante prensas de madera, hierro o acero inoxidable (Menezes 2011).
Ampliamente manufacturado en el Nordeste, se encuentra al Queso “Manteiga” o “Requeijão do Sertão” o “Requeijão del Nordeste”. La producción artesanal de este queso, aún es bastante empírica, presentando amplia variación entre los productores y, consecuentemente, en la composición quí-
197 QUESOS ARTESANALES
mica del mismo. Su proceso consiste, básicamente, en la coagulación de leche entera o descremada, desuerado de la cuajada obtenida por acidificación, con adición de agua o leche y la adición de manteca de la tierra o aceite vegetal a la cuajada fusionada (Cavalcante y Costa 2005; Nassu et al. 2003).
Los quesos “Manteiga” y “Coalho” también se fabrican en la región de Manaus, capital del estado de Amazonas, Región Norte del país. Las metodologías para la elaboración de estos quesos son bastante semejantes a aquellas utilizadas en la Región Nordeste del país. El estado de Pará, produce artesanalmente Queso del Norte y Queso de Marajó. El queso de Marajó se destaca en el escenario de los quesos artesanales en Brasil. Se produce desde hace más de 100 años en la micro-región de Arari-Marajó, en la isla de Marajó, a partir de coagulación espontánea de leche de búfala cruda o de leche de búfala adicionada de leche bovina cruda en proporción máxima de 40%. La cuajada se desuera, se lava con agua o leche y se fusiona en presencia de crema de leche o manteca (Cruz et al. 2015; Simões et al. 2013).
En la región Centro-Oeste, dos estados producen quesos artesanales: Mato Grosso do Sul (Queso Curado y Queso Nicola en el Pantanal sur-MatoGrossense) y Goiás (Cabacinha o Flamengo en la región del municipio de Mineiros).
El movimiento Slow Food Brasil promovió el conocimiento, la valorización y el consumo de quesos artesanales elaborados con leche cruda en el país. Con el objetivo de conocer la diversidad de los quesos artesanales, el movimiento se empeña en el descubrimiento de estos productos y el fruto de este trabajo se presenta en la Figura 1. Sin embargo, existen otros tantos cuyo conocimiento, historia y “modo de hacer” aún no se divulgaron ampliamente.
1.1 Agregando valor al queso Porungo
Como se describió anteriormente, el queso Porungo se produce artesanalmente por decenas de familias en propiedades rurales de la región suroeste del estado de São Paulo (Fig. 2). Hasta hace unos años, casi nada se conocía sobre su manufactura, actores involucrados en el proceso de producción, condiciones socioeconómicas, instalaciones y características fisicoquímicas y microbiológicas del producto.
La literatura científica al respecto es escasa. Con la instalación del campus Lagoa do Sino de la Universidad Federal de São Carlos en Buri, que tiene como uno de sus ejes al desarrollo territorial, los investigadores hallaron en el queso Porungo una oportunidad de conocer el “Estado del arte” de su proceso de elaboración y estudiar estrategias para mejorar su producción y agregarle valor.
La venta de este queso, por el propio productor, continúa realizándose, mayoritariamente, en forma directa al consumidor, en ferias libres o incluso en pequeños mercados y carnicerías, en forma clandestina, ya que el producto no posee registros (Pezzo 2017).
198 DESARROLLO SOSTENIBLE
Queijos Artesanais
do Brasil regiões tradicionais
Queijo Manteiga MANAUS AM
Requeijão Moreno CENT RO GOIANO GO
Queijo Cabacinha ou Flamengo MINEIROS GO)

do




Queijo de Coalho e Queijo Creme (VALE DO JAGUARIBE CE
Queijo Manteiga e Queijo de Coalho SERIDÓ PB/RN)


Requeijão NORT E DE MINAS MG)
Queijo Cabacinha (VALE DO JEQUIT INHONHA MG
Requeijão VALE DO JEQUIT INHONHA- MG)
Queijo Minas Serro (SERRO MG
Queijos Minas Campo das Vertentes (CAMPO DAS VERT
Parmesão da Mantiqueira
Parmesão de Alagoa SERRA
Queijos Minas Canastra
Queijo Minas Araxá ARAXÁ
Queijo Porungo Requeijão de Prato (CENT RO LEST E PAULISTA SP (VALES DO RIBEIRA E
Kochkäse VALE DO ITA AÍ SC
Queijo Diamante MA OR GERCINO SC)
Figura 1. Identificación de quesos artesanales producidos en Brasil. Fuente: Slow Food Brasil (2017).
Durante las investigaciones, se visitaron varias haciendas y sitios de producción, principalmente en los municipios de Angatuba, Buri y Campina do Monte Alegre. En su transcurso, se aplicaron cuestionarios destinados a diagnosticar las características socioeconómicas y culturales, percibiendo que el proceso de elaboración era el mismo en todas las propiedades, destacando la tradición en su producción.
Los queseros, en su mayoría mujeres, relataron que el arte de hacer el queso pasa de generación a generación. Se recolectaron y analizaron microbiológicamente muestras de quesos con el objetivo de conocer el tipo y el número de contaminantes para establecer una correlación con respecto a la seguridad del producto frente al consumo, ya que en su producción se utiliza leche cruda. Los quesos analizados, no contenían Salmonella spp. o Listeria monocytogenes, pero presentaron una elevada carga de Staphylococcus aureus, bacteria naturalmente presente en piel de animales de sangre caliente. Con estos resultados, los productores fueron invitados a participar de un taller donde se presentaron los primeros registros, enfatizando los cuidados en las prácticas higiénicas de producción.
199 QUESOS ARTESANALES www slowfoodbrasil com Brasil Caatinga Pampas Mata Atlântica Pantanal Amazônia Cerrado Legenda Biomas do Brasil Queijinho VALE DO ITA AÍ SC) Queijo Minas Salitre (SERRA DO SALIT RE MG) Queijo Minas Alto Paranaíba (Cerrado) ALTO PARANAÍBA MG) Queijo Colonial (OEST E PARANAENSE PR Queijo Colonial CANT UQUIRIGUAÇU - PR) Queijo Colonial (SUL CATARINENSE PR Queijo Colonial SUDOEST E PARANAENSE PR) Queijo Colonial NOROEST E DO RIO GRANDE DO SUL RS Queijo do Contestado VALE DO CONT ESTADO SC Queijo Colonial OEST E CATARINENSE SC) Queijo Porungo (CAMPOS DAS GERAIS PR) Queijo Curado (PANTANAL - MS
Nicola PANTANAL MS)
Serrano (SERRANA/CAMPOS DE CIMA DA SERRA SC/RS Queijo de Coalho MANAUS AM Queijo Coalho de Cabra (SERTÃO DO SÃO FRANCISCO BA Queijo de Coalho (SERTÃO DOS INHAMUNS E SERTÃO CENT RAL CE Queijo de Coalho e Manteiga AGREST E PERNAMBUCANO PE Queijo de Coalho SERTÃO PERNAMBUCANO PE)
Coalho CURIMATAÚ - PB
Coalho ALTO SERTÃO PARAIBANO PB
ALAGOANO AL) (SERTÃO DO SÃO FRANCISCO SE)
Queijo
Queijo
Queijo de
Queijo de
Queijo de Coalho (CARIRI CEARENSE CE) Queijo de Coalho CARIRI PARAIBANO PB Queijo de Coalho (SERTÃO
Requeijão do Norte e Queijo de Coalho
DO PARAÍBA SP
MG)
SERRA DA CANAST RA MG
ES
ENT
MG)
MANT IQUEIRA MG)
DA
ALAGOA MG)
BA)
do Norte
Triângulo Mineiro T RIÂNGULO MINEIRO MG) Queijo do Norte (BELÉM PA
Queijo
Marajó ILHA DE MARAJÓ PA SERTÃO BAIANO
Queijo de Coalho e Requeijão
Queijo Minas
VALE DO ITA AÍ SC)
Queijo Colonial

Figura 2. Queso Porungo (A) y sus etapas de producción artesanal (B-H). Adición de fermento suero y cuajo a la leche cruda recién ordeñada. Después de la coagulación, la masa es cortada para liberación del suero (B). Drenaje de la masa cuajada (C). Corte de la masa en trozos pequeños (D) y sumersión en agua caliente (E). Estiramiento y moldeo de la masa (F-H). Fotos: Tiago Santi.
El conocimiento del producto se amplió con las investigaciones en torno a sus características fisicoquímicas posibilitando establecer, entre otros parámetros, su contenido de humedad y grasa.
Con el fin de mejorar la calidad de los quesos, los productores fueron nuevamente invitados a participar de un entrenamiento sobre las buenas prácticas de fabricación. Las cartillas fueron entregadas a los productores y, después de un período de implementación de mejoras, las muestras de quesos fueron nuevamente analizadas revelando reducción en los recuentos microbiológicos.
Los datos obtenidos sirvieron de base para que, en colaboración con investigadores de la Unicamp, se proponga al Ayuntamiento Municipal de Angatuba, el Reglamento Técnico de Identidad y Calidad del Queso Porungo, cuya ley fue aprobada y publicada en 2018 y, desde entonces, la comercialización del queso se tornó legal en el Municipio.
200 DESARROLLO SOSTENIBLE
La mejora del producto, asociada a sus características intrínsecas de producción y regulación impulsó su agregado de valor. Con mayor valor agregado, mejores precios pueden ser alcanzados en la comercialización. El aumento de la ganancia sobre el producto generó un mayor interés de los productores para mantenerse en la actividad reduciendo el riesgo de desaparición de este queso ancestral.
Aún restan acciones, especialmente en lo que se refiere a la reglamentación de la elaboración del queso en los demás municipios de producción. La creación de una asociación entre productores es fundamental para el fortalecimiento y la representatividad ante diferentes organismos gubernamentales y no gubernamentales, incluido el acceso a las líneas de financiación.
2. Q UESOS A RTESANALES DE C ORRIENTES (A RGENTINA )
2.1 Diagnóstico de situación
En la provincia de Corrientes, la producción artesanal de quesos “criollos o de campo”, como actividad secundaria a la ganadería, se perpetúa desde los años 1650-1700 y se desarrolla en la mayoría de los establecimientos rurales (Vasek et al. 2011).
El queso artesanal se elabora, en Corrientes, usando metodologías, utensilios y tecnología muy rudimentarios que se transmiten de generación a generación en forma oral. Como materia prima se utiliza leche entera cruda sin maduración, proveniente de vacas criollas, aunque existen algunos productores que cuentan con rodeos de vacas Holando-argentina y Jersey adaptadas a la zona, alimentadas con pasturas naturales y agente coagulante artesanal, obtenido a partir de la inmersión de trozos de cuajar bovino (salado, estaqueado y secado al sol) en leche durante 24 h (Vasek 2003).
La fermentación es espontánea, el corte de la cuajada en granos pequeños se realiza en forma manual y el salado en la masa, antes del moldeo, es mínimo. Los moldes son de materiales variados (hojas de palma cosida, madera, plástico o acero inoxidable) y el prensado es también manual. Los productos resultantes poseen consistencia cremosa a firme, textura semi-cerrada, horma redonda y un peso aproximado de 1-1,5 kg.
La comercialización, a partir de las 24-48 h de elaborados, se realiza por vías informales sin estar sujeta a controles de calidad higiénicos-sanitarios, ni a normas de elaboración que permitan obtener un producto tipificado. Los mismos se exhiben para la venta a temperatura ambiente conjuntamente con diversos productos de granja de origen vegetal (maníes, maíz, zapallos, plantas ornamentales) y animal (huevos, miel), sin cubierta protectora, en mercados frutihortícolas y a la vera de los caminos (Vasek et al. 2008a).
La metodología descrita evidencia que estos quesos poseen calidad variable desde el punto de vista higiénico-sanitario, fisicoquímico y sensorial, que se traduce en una desventaja económica para los productores queseros
201 QUESOS ARTESANALES
y esta micro-industria local, por la imposibilidad de efectuar una comercialización seria y constante en el tiempo, que aumente su volumen de producción-venta y mejore su situación socio-económica. Sin embargo, estos quesos artesanales tienen un volumen de producción apreciable y un requerimiento interesante por parte del mercado, el cual podría ser aún más prometedor en la medida en que se ofrezca al consumidor un producto seguro y, de calidad uniforme y constante.
En una sociedad particularmente tradicionalista y conservadora como la de Corrientes, la mujer rural es una subordinada del esposo que no siempre es “su compañero”, considerándose de ella su capacidad reproductora y en algunas ocasiones su capacidad organizativa y de subsistencia del hogar en relación a las tareas domésticas y seguridad alimentaria. Por esta razón, desarrolló estrategias adaptativas como la elaboración de productos caseros para autoconsumo y para generar un ingreso adicional, a fin de amortiguar el impacto que en ella causan las situaciones antes mencionadas. Los inconvenientes se relacionan con la comercialización ya que, en pocas oportunidades recibe el beneficio económico real de su trabajo.
En principio, prefieren vender sus quesos a la vera del camino estableciendo casi un “puesto” permanente, siempre y cuando su granja se ubique a la vera de un camino con tránsito más o menos regular, que atienden mientras continúan con sus tareas y al que pueden contribuir sus hijas mujeres. En esta forma de venta fijan su precio y el regateo se realiza directamente con el comprador interesado. En las épocas de excedente de quesos, se trasladan hasta la ciudad para ofrecerlos en el mercado o inmediaciones del mismo como cuentapropistas, ya que la ganancia sigue superando a la venta con intervención de un puestero del mercado frutihortícola. Recién en tercera instancia acuden a estas personas con puestos fijos en el mercado, regateando el precio en lengua mezcla de castellano y guaraní.
La transmisión de este “saber-hacer” de madre a hija, no sólo implica los secretos del conocimiento en su iniciación temprana en la casa paterna, sino también los secretos del saber vender. En esta transmisión, el saber hacer y el saber vender se enseñan y aprenden mirando, escuchando y despertando la agudeza para asimilar rápidamente las situaciones y plantear las estrategias según las características del puestero (Vasek et al. 2011).
Se destaca, que la afluencia turística local, nacional e internacional a la provincia de Corrientes en diferentes épocas del año imprime un sello particular para los visitantes en busca de productos regionales, particularmente los quesos de campo. Esta afluencia turística incluye un abanico de fiestas religiosas católicas (Virgen de Itatí, San Luisito Rey de Francia y La cruz de los Milagros) y de culto popular no comprendido en la liturgia católica (Fiesta del Gauchito Gil). Asimismo, el turismo deportivo de pesca en las Fiestas Nacionales del Dorado, del Surubí y del Pacú, otras fiestas como la Fiesta Nacional del Chamamé y el Carnaval Correntino, a las cuales se suma la gran reserva natural
202 DESARROLLO SOSTENIBLE
hídrica que forman los Esteros del Iberá, constituyen otro recurso de venta y promoción para los artesanos queseros cuyos establecimientos se ubican en las zonas rurales aledañas.
Para profundizar en el sentido social y, siguiendo el método del Marco Lógico (Sánchez 2007), se construyó el Árbol de Problemas y la matriz de involucrados para el esclarecimiento de la situación problemática a fin de planificar una estrategia de mejora en función del modelo de política científicotecnológica del Triángulo de Sábato. El árbol de problemas, en una de las zonas de producción que representa sólo el 1% del total de la provincia de Corrientes (Argentina) con una superficie de 890 km2 longilínea sobre la costa del rio Paraná, señaló que la causa raíz de la “limitada situación productiva, social y económica de estos queseros” es el analfabetismo. Este escenario, mediante una cadena de situaciones, no permite que estos productores vean y, en consecuencia, programen alternativas para mejorar su productividad, competitividad y posición socio-económica, resultando en una escasa explotación de la actividad quesera y una comercialización no sustentable en el tiempo, que generó y mantiene su escaso desarrollo económico (Vasek y Falcione 2013).
2.2 El agregado de valor
La propuesta de elaborar un producto final que, sin perder sus características artesanales resulte seguro, pueda ser tipificado y comercializado, y que permita el desarrollo de este sistema agroalimentario localizado, incluyó abordar el tema desde aspectos tecnológicos y sociales diversos, planteando esta situación bajo la premisa de respetar las materias primas y procedimientos artesanales, la calidad organoléptica original, la seguridad higiénico-sanitaria y la obtención de características comerciales uniformes. Se buscaron alternativas de mejora, aprovechando este recurso alimentario zonal para promover la calidad nutricional de la población regional, mediante la transformación de su actividad productiva actual secundaria en actividad principal, aumentando su productividad y competitividad.
La composición fisicoquímica de la leche cruda presentó buena aptitud quesera, siendo innecesaria su complementación proteica o de calcio y mostró variaciones no significativas a lo largo del año (Cardozo et al. 2003). Desde el punto de vista microbiológico, se evidenciaron deficiencias higiénico-sanitarias durante el ordeñe, sin detectar bacterias de riesgo para la salud humana (Lancelle y Vasek 2002).
Las características fisicoquímicas de estos quesos (Vasek et al. 2008b), los clasificaron como “queso graso de muy alta humedad” (MERCOSUR GMC Nº 79/94). Si bien las poblaciones de bacteria lácticas (BAL), constituyeron el grupo predominante, presentes en órdenes mayores a 108 ufc g-1, de acuerdo con la carga contaminante (Pereira et al. 1995, Vasek et al. 2004), estos quesos pueden considerarse como inseguros desde el punto de vista higiénico clasificándose como inaceptables (MERCOSUR GMC Nº 69/93). Bajo este punto de
203 QUESOS ARTESANALES
vista microbiológico, con elevados recuentos bacterianos causados por prácticas deficientes de manipulación y contaminación ambiental, es necesaria la implementación de medidas para asegurar la salud de los consumidores.
Estos quesos se comercializan a distintos tiempos de maduración, generalmente frescos, pero en los últimos tiempos algunos productores utilizan estacionamientos de hasta 1mes, particularmente al final del período de mayor producción (Primavera-Verano). La cinética de crecimiento de las poblaciones microbianas durante 30 días de maduración (Vasek et al. 2013) mostró que los microorganismos indicadores de condiciones higiénico-sanitarias, estuvieron presentes en números elevados, la ausencia de control en las condiciones ambientales de maduración mantuvieron parámetros intrínsecos (elevada humedad y pH) poco restrictivos para la propagación de microorganismos adventicios indeseables durante la manufactura y maduración de los quesos.
La carga de Mohos, disminuyó sin detectarse a los 15 días; sin embargo, las condiciones desarrolladas en el interior de los quesos permitieron la proliferación de levaduras que incrementaron su número durante el período estudiado. Los agentes etiológicos de enfermedades transmitidas por alimentos permanecieron durante 30 días de maduración, representando un riesgo sanitario para la Salud Pública. Incuestionablemente, 30 días de maduración proveen mejor calidad higiénica debido a la disminución de la carga microbiana, pero dada la falta de control en los puntos de venta, la calidad higiénicosanitaria de estos quesos no puede garantizarse. Sin embargo, no existen datos epidemiológicos registrados en la Provincia, referentes a enfermedades que involucren a estos quesos artesanales como vehículo de tóxico-infección.
La selección de bacterias lácticas con capacidades tecnológicas adecuadas con vistas a diseñar un cultivo iniciador, mejoraría la calidad biológica intrínseca y contribuiría al agregado de valor a estos productos. La distribución según el género de las BAL autóctonas integrantes de este sistema de transformación fue lactococos, lactobacilos y leuconostocs que representaron el 68, 20 y 11% del total de BAL, respectivamente, a las 24 h de manufactura. Estos porcentajes se modificaron en valor absoluto, aunque la relación de dominancia se mantuvo durante toda la manufactura y maduración de los quesos hasta los 30 días (Vasek et al. 2013).
En este sentido, el nicho ecológico de la provincia de Corrientes, ofrece un ecosistema particular en referencia a BAL, dado que no existe contaminación con cepas comerciales por la ausencia de producción quesera a escala industrial. Los componentes de este sistema biológico constituye la base fundamental para el empleo de microorganismos silvestres en Sistemas Agroalimentarios Fermentativos Localizados.
2.2.1 Diseño de un cultivo iniciador autóctono
A partir de las capacidades tecnológicas evaluadas en las cepas de BAL autóctonas (elevada acidificación, producción de compuestos antimicrobia-
204 DESARROLLO SOSTENIBLE
nos, actividad proteolítica, formación de compuestos del aroma, entre otros), se formularon 54 posibles fermentos lácticos (Vasek et al. 2000).
Los ensayos de producción de quesos a escala de laboratorio y de producción artesanal, destacaron la preferencia sensorial de uno de ellos que mantenía las características del producto original sin fermento, para los análisis sensoriales también participaron los queseros de la zona (Vasek 2003; Vasek et al. 2011). Este trabajo valió el Reconocimiento del Ministerio Nacional de Ciencia y Tecnología de Argentina al Grupo I+D+i BiMIA, como capacitado para cubrir, biotecnológicamente la “Demanda Destacada del Sector Alimentos, Bebidas y Tabacos: Desarrollo de fermentos autóctonos para la producción de quesos regionales saludables” (Innovación Argentina 2015).
Por otra parte, el conocimiento de la función de las Levaduras en este ecosistema, mostró que algunas de ellas tienen elevada actividad lipolítica, lo cual contribuiría a la producción de compuesto del sabor-aroma y que degradan aminas biógenas que podrían formarse ocasionalmente durante la maduración de estos quesos, contribuciones positivas que merecerían su evaluación para integrarlas como adjunto a un potencial cultivo iniciador (Cardozo 2011).
2.2.2 Estandarización del agente coagulante
Se evaluó el modo para estandarizar el secado de los cuajares destinado a la preparación del agente coagulante, empleando salmueras de distintas concentraciones y sal seca (NaCl) con distintas relaciones cuajar:salmuera o cuajar:sal, evaluando el tiempo de secado a la intemperie, la humedad final y la carga microbiana (Erro et al. 2002, Lancelle et al. 2003).
Dado que las condiciones ambientales (elevada humedad y temperatura) influyen desfavorablemente en el proceso de secado, se diseñó un secadero para cuajares (Fig. 3) de fácil construcción y asequibles materiales, accesible económicamente a todos los productores (Schvorer et al. 2012).
Posteriormente se determinó la relación cuajar seco:sustrato (leche) que logra extraer mayor cantidad de enzima coagulante y el tiempo de uso de este coagulante, conservado en condiciones de refrigeración, determinando la fuerza del agente coagulante en el tiempo y su relación con el empleo de coagulante comercial (Valenzuela López et al. 2015).
Los resultados permitieron estandarizar esta preparación en: estómagos de bovino adulto + NaCl (granulometría entrefina) en relación 1+2 p/p se secan en el secadero logrando una humedad final de 5%. Empleando la relación cuajar:leche cruda: 60 g L-1 con inmersión durante 24 h a temperatura ambiente, el suero exudado se guarda en un frasco limpio, con tapa y a temperatura de refrigeración para su uso seguro, desde el punto de vista tecnológico y microbiológico, durante un máximo de 7 días.
205 QUESOS ARTESANALES



Figura 3. Secadero para cuajares bovinos construído de madera estacionada impermeabilizada, con sistema de calefacción generado por bombillas de luz, homogeneización del aire caliente mediante provisión de dos circuladores de aire internos y detector LED externo. A) vista interior superior, B) vista interior frontal, C) vista exterior total.
2.3 Transferencia a los productores queseros
Durante estos años, fue necesaria la participación de la Universidad en la sociedad regional en forma permanente. Con el fin de promover mejoras en este sistema agroalimentario, dada la idiosincrasia del habitante rural, este proceso resulta largo y paulatino, donde en primera instancia es necesario adecuarse a su lenguaje, tiempos y creencias.
La Universidad Nacional del Nordeste (UNNE) participó en diferentes programas de extensión contando con la participación del Instituto de Cultura Popular y el Instituto de Tecnología Industrial (INTI-Lácteos-Rafaela) desa rrollando actividades conjuntas con los productores. La ejecución de charlas, jornadas demostrativas, entrega de material de divulgación escrito, permitió estrechar la vinculación con estos actores (Fig. 4), con la meta primaria de mejorar las prácticas higiénicas durante la obtención de leche y la elaboración de estos quesos, a la vez de sembrar la idea del empleo del fermento láctico autóctono y la estandarización para la preparación del agente coagulante artesanal (Falcione et al. 2016).
2.4 Valorización comercial
Para otorgar mayor relevancia a estos productos, se obtuvo la Declaración de los Quesos Artesanales como Patrimonio Histórico, Social y Cultural de la provincia de Corrientes (Res. 1354 del 1/12/16, Instituto de Cultura de la Provincia), reconocido por parte del Consejo Directivo de la Facultad de Ciencias Exactas y Naturales y Agrimensura de la UNNE (Res.0312/17), y por la Honorable Cámara de Diputados de Corrientes (Dec. 05/18 del 21/02/18).
206 DESARROLLO SOSTENIBLE A B C



Figura 4. Actividades conjuntas con productores. A) Reunión organizativa en la granja de un productor, B) Taller dictado en la Facultad de Ciencias Exactas y Naturales y Agrimensura-UNNE, C) Jornada demostrativa de producción en la granja de un productor.
2.5 Difusión pública
Con el fin de dar a conocer públicamente las bondades que otorga el uso del fermento autóctono a las características organolépticas, se produjeron lotes de quesos con y sin fermento que se ofrecieron para degustación en distintos eventos sociales, culturales y técnico-científicos (Fig. 5).



Figura 5. Manufactura de quesos artesanales con y sin fermento autóctono y posterior degustación. A) Producción de quesos en la granja X. B) Presentación de los quesos para degustación. D) Degustación durante la promoción del fermento en la ciudad de Sáenz Peña.
CONSIDErACIONES FINALES
Brasil es un país extenso no sólo en territorio, sino también en la diversidad de quesos artesanales producidos en sus diferentes regiones. Muchas investigaciones académicas ya se realizaron, especialmente sobre los Quesos
207 QUESOS ARTESANALES
C
A B
A B C
Minas Artesanales, las mismas discriminaron las características de cada queso, respondiendo a la necesidad de la implementación de rigurosas prácticas higiénico-sanitarias que fomentaron tanto la mejora de los procesos productivos como la creación de leyes de regulación y protección de los quesos. Hoy, el producto tiene un alto valor agregado y el precio del kilo de queso se elevó sustancialmente. Así, la renta de las familias aumentó y los jóvenes, hijos de los productores que antiguamente querían dejar las zonas rurales, ven futuro en la producción de los quesos. La historia del desarrollo de los quesos Minas Artesanales sirve hoy de inspiración para tantos otros quesos esparcidos por la Nación que buscan recorrer los mismos pasos que llevaron este queso al nivel en que se encuentra actualmente.
El modelo de política científico-tecnológica conocido como el Triángulo de Sábato, basado en las teorías de mejora socio-económica y las posibilidades de superar la línea de pobreza, postula que para que este modelo exista realmente, el sector que diseña y ejecuta la política (el estado), el sector que ofrece conocimientos-tecnología (las Universidades e Institutos de Investigación) y el sector demandante de estos conocimientos científico-tecnológicos y de su transferencia (las Empresas y productores) deben mantener, necesariamente, fuertes, asiduas y dinámicas interrelaciones que generen interdependencia.
Sobre la base del benchmarking, considerando a los líderes mundiales en producción de quesos artesanales donde se incluyen varios países de Europa como España, Francia, Italia, Eslovaquia, entre otros, el análisis de un agronegocio permitiría a la cadena productiva: conocer la situación del mercado actual, establecer las posibilidades de desarrollo de estos productos e identificar posibles mercados.
La BDP es “mercado virgen”, transformando la concepción de escala de “cuanto mayor, mejor” a una estrategia a pequeña escala combinada con capacidades globales como I+D+i, cambiando el modelo tradicional uso intensivo de capital-eficiencia laboral por uso eficiente del capital e intensivo del trabajo, construyendo relaciones poco tradicionales con los gobiernos locales, micro -empresas familiares y Organizaciones Sociales Civiles, relacionándose con el contexto local como capital social para superar la ausencia de instituciones formales que protejan derechos de propiedad intelectual y aseguren el respeto de las leyes.
Considerando estas postulaciones y su reflexión, se propondría una estrategia de co-creación de valor, manteniendo las bases del Triángulo de Sábato, formulándolo como modelo de negocios inclusivo y generado-dirigido a la BDP, para mejorar la capacidad productiva y, consecuentemente, el nivel socio-económico de los integrantes de estos nichos de quesos ancestrales, sin perder el carácter artesanal, sus características peculiares sápido aromáticas y el saber-hacer propio de estos productores, fundamentada en la gestión para la vinculación de los distintos actores involucrados, y que podría ampliarse a otras regiones de Argentina y Brasil.
208 DESARROLLO SOSTENIBLE
REFERENCIAS BIBLIOGRÁFICAS
Almeida SL, Júnior FGP, Guerra JRF (2013) Representação da produção e consumo do queijo coalho artesanal. Revista Interdisciplinar em Cultura e Sociedade, 2:37-58.
Azevedo VMR et al. (2015) Un mercado creciente de US$750 mil millones. Descubriendo oportunidades en la base de la pirámide en América Latina y el Caribe. Banco Interamericano de Desarrollo. http//:www.creativecommons.org/licenses/by-nc-nd/3.0/igo/legalcode. Acceso Febrero 2019.
Bánkuti FI et al. (2017) Potencialidades tecnológicas e qualidade da cadeia produtiva do queijo colonial na região Sul do Brasil: uma revisão. FTT Journal of Engineering and Business, 1:50-64.
Cardozo MC, Vasek OM, Fusco AJV (2003) Composición físico-química de leche usada para la elaboración de Quesos Artesanales de Corrientes. http:// www.unne.edu.ar/cyt/2003/cyt.htm. Acceso Diciembre 2018.
Cardozo MC (2011) Flora de levaduras en Quesos Artesanales de Corrientes, su actividad bioquímica y su interacción con bacterias de starters. PhD Disertación UNNE.
Carrara AA (2000) A capitania de Minas Gerais (1674-1835): modelo de interpretação de uma sociedade agrária. História econômica & história de empresas, 3:647-633.
Carvalho MM (2015) A agroindústria familiar rural e a produção de queijos qrtesanais no município de Seara, Estado de Santa Catarina-Um estudo de caso. Dissertation. Universidade Estadual do Oeste do Paraná, campus Marechal Cândido Rondon.
Castro HM, Deus JAS, Silva PHC (2012) Agricultura familiar e suas interações com a produção de alimentos tradicionais na região central de Minas Gerais: Retrospectiva histórica e dinâmica atual dos processos. XXI Encontro Nacional de Geografia Agrária. Uberlândia, Brasil. http://www.lagea.ig.ufu. br/xx1enga/anais_enga_2012/eixos/1016_2.pdf. Acceso abril 2019.
Carrara AA (2000) A capitania de Minas Gerais (1674-1835): modelo de interpretação de uma sociedade agrária. História económica & história de empresas, 3(2):47-63. doi.org/10.29182/hehe.v3i2.138.
Cavalcante ABD, Costa JMC (2005) Padronização da tecnologia de fabricação do queijo manteiga. Revista Ciência Agronômica, 36:215–220.
Cruz BEV et al. (2015) A identificação geográfica para o Queijo do Marajó com estratégia de desenvolvimento territorial para a microrregião do Arari-Marajó, PA. Cadernos de Prospecção, 8:158-168.
Dallabrida VR, Tabasco JJP, Pulpón, ARR (2018) Agricultura familiar, organização de produtores e desenvolvimento territorial: oportunidades e ameaças em experiências agroalimentares no Estado de Santa Catarina (Brasil). Redes (Santa Cruz do Sul) 23:135-153. doi: 10.17058/redes.v23i2.12083.
Dores MT, Ferreira CLLF (2012) Queijo minas artesanal, tradição centenária: ameaças e desafios. Revista Brasileira Agropecuária Sustentável, 2:26-34.
Erro MG, Vasek OM, Fusco AJV (2002) Preparación de cuajo artesanal en queserías de la Provincia de Corrientes. http://www.unne.edu.ar/cyt/2002/cyt. htm. Acceso 25 Marzo 2019.
209 QUESOS ARTESANALES
Falcione LF, Valenzuela López JA, Sin CS et al. (2016) Intercambio de experiencias productivas sobre quesos artesanales en San Luis Del Palmar, Corrientes. Extensionismo, Innovación y Transferencia Tecnológica-Claves para el Desarrollo, 2:157-161.
IMA (2018) Legislação Queijo Minas Artesanal. Instituto Mineiro de Agropecuária. http://www.ima.mg.gov.br/certificacao/queijo-minas-artesanal. Acceso 19 Marzo 2019.
Innovación Argentina (2015) http//:www.innovacionargentina.gob.ar/transferencia/demandas-de-innovacion. 2015. Acceso Marzo 2019.
IPHAN (2014) Modo artesanal de fazer queijo de Minas: Serro, Serra da Canastra e Serra do Salitre (Alto Paranaíba). Instituto do Patrimônio Histórico e Artístico Nacional. http://portal.iphan.gov.br/uploads/publicacao/Dossie_ Queijo_de_Minas_web.pdf. Acceso Abril 2019.
Lancelle MaV, Vasek OM, Fusco AJV (2003) Composición microbiológica del agente coagulante artesanal de Corrientes. http://www.unne.edu.ar/ cyt/2003/cyt.htm. Acceso Enero 2019.
Lancelle MaV, Vasek OM (2002) Calidad microbiológica de leche cruda usada en queserías de la provincia de Corrientes. http://www.unne.edu.ar/ cyt/2002/cyt.htm. Acceso 18 Febrero 2019.
Menezes S (2011) Queijo de coalho: tradição cultural e estratégia de reprodução social na região Nordeste. Revista Geográfica Acadêmica, 28:40-56.
M ERCOSUR . Reglamento Técnico General (1993) Res. GMC Nº. 69/93. Requisitos microbiológicos para quesos.https://www.argentina.gob.ar/sites/default/files/capitulo_viii_lacteosactualiz_2019-03.pdf Acceso Marzo 2019.
MERCOSUR. Reglamento Técnico General (1994) Res. GMC Nº79/94. Identidad y Calidad de Quesos. https://www.argentina.gob.ar/sites/default/files/capitulo_viii_lacteosactualiz_2019-03.pdf Acceso Marzo 2019.
Mozdzenski L, Silva BA (2019) De portas abertas para o consumo. Signos do Consumo, 11: 84-97. doi:10.11606/issn.1984-5057.v11i2p84-97.
Mutis J, Ricart JE (2008) Innovación en modelos de negocio: La Base de la Pirámide como campo de experimentación. Universia Business Review, 2:10-27. Nassu RT et al. (2003) Diagnóstico das condições de processamento e caracterização físico-química de queijos regionais e manteiga no Rio Grande do Norte. Embrapa Agroindústria Tropical, Fortaleza. https://ainfo.cnptia.embrapa.br/digital/bitstream/CNPAT-2010/9006/1/Bd-011.pdf. Acceso Abril 2019.
OECD-FAO (2016) Agricultural Outlook 2016-2025. http//:www.oecd-ilibrary. org/agriculture-and-food/oecd-fao-agricultural-outlook-2016-2025. Acceso Enero 2018.
OECD-FAO (2015) Agricultural Outlook 2015-2024. http//:www.oecd-ilibrary. org/agriculture-and-food/oecd-fao-agricultural-outlook-2015-2024. Acceso Enero 2019.
Pereira MaC, Vasek OM, Fusco AJV (1995) Quesos Artesanales de Corrientes (Argentina). Microflora contaminante. FACENA, 11:85-91.
Pereira BP et al. (2014) Implicações do processo produtivo na qualidade do Queijo Artesanal Serrano. evista Eletrônica em Gestão, Educação e Tecnologia Ambiental, 18:116-126. doi:10.5902/2236117013183.
210 DESARROLLO SOSTENIBLE
Perondi MA, Dengo AB, Gazolla M (2019) Mercados das agroindústrias familiares de queijo artesanal do Sudoeste do Paraná. Redes (Santa Cruz do Sul. Online) 24:246-269. doi:10.17058/redes.v24i1.11895.
Pezzo M (2017) Porungo: queijo tradicional da região do Campus Lagoa do Sino está no centro de parcerias entre pesquisadores e produtores locais. Revista UFSCar, 2:36-41.
Prahalad CK (2010) Las mejores prácticas tienen límites. Harvard Business Review, 88(3):26.
Ries JE, da Luz JCS, Araújo S (2012) Projeto de qualificação e certificação do Queijo Serrano produzido nos Campos de Cima da Serra do Rio Grande do Sul. Agroecologia e desenvolvimento rural sustentável, 5:10-19.
Sakr MR, Dallabrida VR (2015) Produtos de Santa Catarina com identidade territorial. Revista de Política Agrícola, 3:102-113.
Sánchez N (2007) El marco lógico. Metodología para la planificación, seguimiento y evaluación de proyectos. Visión Gerencial, 6(2):328-343.
Santos JS (2014) Valorização de produtos alimentares tradicionais: um estudo a partir do queijo do Serro, Minas Gerais, e do queijo Serrano, Rio Grande do Sul. Revista Geonordeste, 2:8-24.
Santos Filho AS et al. (2017) Caracterização física e condições sanitárias do comércio de queijo Cabacinha em três municípios do Vale do Jequitinhonha, MG, Brasil. Revista do Instituto de Laticínios Cândido Tostes, 71:219-227
Santos SK (2017) Os territórios de governança e suas redes geográficas: estudo sobre o desenvolvimento do turismo rural nos Campos Gerais/PR, Brasil e Comunidade Auntônoma de Aragão, Espanha. Tese. Universidade Estadual de Ponta Grossa.
Schvorer GF, Vasek OM, Fusco AJV (2012) Variables microbianas como control de funcionamiento en un secadero de cuajares salados MICROAL. Anales del XI Congreso Latinoamericano de Microbiología e Higiene de los Alimentos. Buenos Aires, Argentina, 8:225-226.
Silva OP (1995) A mineração em Minas Gerais: passado, presente e futuro. Geonomos, 3:77-86. doi:10.18285/geonomos.v3i1.217.
Simões MG et al. (2013) Effect of bovine milk addition to buffalo’s milk on different characteristics of artisanal Marajó “cream cheese” type. Revista do Instituto de Laticínios Cândido Tostes, 68:32–40.
Slow Food Brasil (2017) Queijos artesanais brasileiros. http://www.slowfoodbrasil.com/campanhas/queijos. Acceso Febrero 2017.
Valenzuela López JA et al. (2015) Comparación tecnológica de agente coagulante artesanal y comercial en la maduración de quesos. Anales del Simposio Lácteos y Salud. Campinas, SP, ITAL, pp. 1-5.
Vandecandelaere E et al. (2010) Uniendo personas, territorios y productos: Guía para fomentar la calidad vinculada al origen y las indicaciones geográficas sostenibles. FAO y SINER-GI, Roma, Italia. 194p.
Vasek OM (2003) Fermento autóctono para la elaboración de queso artesanal de Corrientes. PhD Disertación UNNE.
Vasek OM, Fusco AJV, Giori G de (2000) Formulación de un fermento para la elaboración de Queso Artesanal Correntino. Información tecnológica, 11(6):65-71.
211 QUESOS ARTESANALES
Vasek OM et al. (2004) Análisis de riesgos en la elaboración de queso artesanal de Corrientes (Argentina). FACENA, 20:13-22.
Vasek OM, Cardozo MC, Fusco AJV (2008a) Producción artesanal de quesos. Sistema de transformación agroalimentario en la Región Correntina (Argentina). Anales del IV Congreso Internacional de la Red SiAL. Mar del Plata, Argentina 3:1-32
Vasek OM et al. (2008b) Chemical composition and microbial evaluation of Argentinean Corrientes Cheese. International Journal of Dairy Technology, (3):222-228.
Vasek OM, Cardozo MC, Fusco AJV (2011) Procesos de Innovación: El caso de los Quesos Artesanales de Corrientes. In: De la leche al queso: queserías rurales en América Latina. IICA-CIRAD. MA Porrúa, México, pp.199-223.
Vasek OM, Falcione LF (2013) Strategy co-creation value for cheese production in Ramada Paso-Itatí, Corrientes, Argentina, exploiting the local food resource. Proceeding VI Congresso Internacional Sistemas Agroalimentares Localizados. Florianópolis, Brasil, 2:1-29.
Vasek OM, Mazza SM, Giori GS de (2013) Physico-Chemical and microbiological evaluation of Corrientes Artisanal Cheese during ripening. Food Science and Technology, 33(1):151-160.
212 DESARROLLO SOSTENIBLE
ECONOMÍA CIRCULAR: VALORIZACIÓN DE RESIDUOS ORGÁNICOS PROVENIENTES DEL SECTOR
AGROALIMENTARIO
Gabriela Cristiano
Universidad Nacional del Sur (UNS), Departamento de Economía, Instituto de Investigaciones Económicas y Sociales del Sur (IIESS/CONICET), San Andrés 800, Campus Altos del Palihue, (8000) Bahia Blanca, Argentina. E-mail: gcristiano@uns.edu.ar
INTRODUCCIÓN
Las actividades productivas vinculadas al sector agroalimentario generan residuos orgánicos, los que podrían ser sometidos a un cierto tratamiento de modo tal de mitigar los impactos negativos que estos provocan al medio ambiente. En este trabajo, se presenta una metodología que permitiría transformar los residuos biomásicos en biofertilizantes con el objetivo de valorizarlos, es decir, como una alternativa para el desarrollo económico y simultáneamente, para el cuidado del medio ambiente.
De este modo, las empresas podrán obtener un nuevo producto (un biofertilizante para ser comercializado o utilizado en su propio establecimiento) a partir de esos residuos, los que serán empleados como inputs para obtener nuevos outputs. Este tratamiento conllevará a mitigar considerablemente las externalidades negativas de actividades generadoras de residuos orgánicos, dando lugar a una nueva modalidad de producción sustentable con el medioambiente. Esta modalidad consiste en un nuevo modelo económico de producción, denominado economía circular.
El término “economía circular” se utilizó por primera vez en 1980 para describir un sistema cerrado de las interacciones entre economía y medio ambiente. Este nuevo concepto consiste en una alternativa fiable y plausible para desarrollar un nuevo modelo que permita propiciar una sociedad altamente sustentable y respetuosa del ambiente para modificar un modelo económico en crisis (Martínez y Porcelli 2019).
1. MArCO DE rEFErENCIA
Los estudios de índole económica sobre los recursos naturales y el medioambiente, los cuales han cobrado importancia en los últimos tiempos, suelen considerar tres ejes relevantes al momento de efectuar un análisis en relación a los mismos: la contaminación ambiental, la extracción de recursos-
Stadnik MJ, Velho AC, Zorrilla SE (eds.) Desarrollo Sostenible en la Producción Agroalimentaria
213
13
sean renovables o no, y la valoración ambiental (Aguilera Klink y Alcántara 2011). En este sentido cabe preguntarse, primeramente, qué se entiende por “medioambiente”.
El medioambiente constituye ese espacio dual en el que los individuos realizan todas sus actividades productivas y toman de él los recursos necesarios para transformarlos en productos finales con mayor o menor grado de valor agregado. Sin embargo, por otro lado, ese mismo ambiente es el que recibe todos los residuos que generan tanto los productores como los consumidores. Surge entonces la economía ambiental, la cual tiene sus raíces en la teoría neoclásica. Uno de los temas centrales de la economía ambiental es el tratamiento de las externalidades (en el que se analiza la valoración monetaria de los beneficios y costos ambientales) y el estudio relacionado a la problemática del agotamiento de los recursos no renovables vinculado a la cuestión de la asignación óptima intergeneracional (Aguilera Klink y Alcántara 2011).
Arthur Pigou (1920) es considerado el precursor de la Economía del Bienestar y el principal pionero del movimiento ambiental. Distinguió los costos privados de los sociales, como así también los beneficios privados y sociales, planteando al problema de las externalidades desde una óptica unilateral; esto implica que un agente –productor o consumidor– causa un perjuicio o beneficio a otro y por esta razón debe ser compensado o penalizado. El actor capacitado para resolver estas externalidades según Pigou es el Estado, el cual (dado un determinado marco legal), a través del cobro de impuestos o del otorgamiento subsidios puede prohibir/disminuir o incentivar la producción o el consumo de los bienes en cuestión. A modo de ejemplo cabe mencionar que el Estado podría sancionar a una empresa que contamina por medio de la aplicación de un impuesto, de modo de obligarla a internalizar esa externalidad negativa.
Estos impuestos que permiten corregir esos efectos negativos se conocen como impuestos piguvianos. Esta sería una forma de incluir, mediante el impuesto, el costo externo provocado a la sociedad en la función de costo privado que posee la firma. Esta propuesta no necesariamente eliminaría por completo la externalidad (sí podría hablarse de un nivel óptimo de producción). Por otra parte, habría que plantearse que si se anulase por completo ese efecto externo (contaminación), no existiría la producción de ese bien, razón por la cual se debería analizar a posteriori qué tan beneficiosa es esta nueva situación para la sociedad en su conjunto (Pigou 1920, en Aguilera Klink y Alcántara 2011).
La otra aproximación general a las posibles soluciones al problema de las externalidades se deriva de la propuesta general enunciada por Ronald Coase (1960), popularizada posteriormente por George Stigler bajo el nombre de Teorema de Coase. Ésta postula que siempre será posible obtener, bajo ciertas condiciones y a través de la negociación, un equilibrio óptimo entre las necesidades de la sociedad y las inevitables externalidades que se generan en
214 DESARROLLO SOSTENIBLE
la producción, indispensables para satisfacerlas. Coase avanza en el análisis y, a diferencia a Pigou, considera que el problema de las externalidades puede llegar a ser un problema recíproco, donde ambas partes estén involucradas (Coase 1960, en Aguilera Klink y Alcántara 2011).
Coase (1960) plantea que el problema de los beneficios y de los costos externos no radica específicamente en el hecho de que sean externos, sino en los derechos de propiedad, que en este caso son imprecisos e indeterminados, y en los costos de transacción, los cuales son elevados. Si estos derechos de propiedad estuvieran claramente definidos y si el número de partes involucradas fuera reducido y los costos de transacción fueran bajos, podría así concluirse que las transacciones son eficientes (Coase 1960, en Aguilera Klink y Alcántara 2011). De esta manera, las externalidades se mantendrían internalizadas. En este caso, el mercado puede ser eficiente incluso cuando existieran externalidades. Por lo tanto, las negociaciones privadas asegurarían un equilibrio de mercado eficiente. Sin embargo, es bastante difícil que ocurran las condiciones para que el Teorema de Coase pueda cumplirse. Es por esta razón que a partir de él se desprende un enfoque alternativo para dar solución al problema de las externalidades: la creación de nuevos mercados. A modo de ejemplo, y siguiendo a Eskeland y Jiménez (1992) puede decirse que cuando la contaminación se dispersa uniformemente, es posible mejorar o proteger la calidad del medio ambiente controlando las emisiones. Un adecuado marco institucional contribuiría a mitigar las emisiones y no permitiría que las partes intervinientes negociaran el derecho a contaminar. Por otro lado, cuando existen estímulos basados en el mercado, tales como los permisos negociables, los subsidios a la reducción de contaminación y los impuestos a las emisiones, se generan señales para todas las fuentes contaminantes al incrementarse los costos de producción. Todos estos instrumentos permiten que el mercado distribuya la reducción de la contaminación donde sea menos costosa.
En relación a lo anteriormente expuesto, pareciera ser que existe una disyuntiva entre los mecanismos de dirección y control y los estímulos basados en el mercado. Generalmente, las políticas de dirección y control llevadas a cabo por un ente regulador no suelen ser muy efectivas cuando existen muchos contaminadores heterogéneos, un amplio sector productivo informal y una administración pública débil, características que son propias de los países en vías de desarrollo. Puede decirse entonces que la teoría económica neoclásica resuelve la problemática vinculada a las externalidades negativas de producción por medio de:
• La aplicación de impuestos;
• La asignación de derechos de propiedad;
• El mercado (comercialización de permisos negociables).
215 ECONOMÍA CIRCULAR
2. rESIDuOS AGrOPECuArIOS
Los residuos agropecuarios son considerados en general de naturaleza orgánica. Como tales, comparten características similares con otros residuos de origen agroindustrial y con la parte orgánica de los residuos sólidos urbanos. A diferencia de los residuos agroindustriales, estos se producen en su entorno natural, mientras que los otros son generados en procesos de transformación de productos agrícolas; en tanto, los urbanos se generan en el proceso de consumo, junto con otros no orgánicos. Los residuos agropecuarios, a su vez, pueden clasificarse en:
• Residuos agrícolas;
• Residuos forestales;
• Residuos ganaderos;
• Residuos de industrias agropecuarias/agroalimentarias.
Los residuos agropecuarios presentan algunas propiedades favorables que pueden dar origen a su aprovechamiento en los sectores energético, agrícola, ganadero e industrial. Entre esas propiedades se hallan el poder calorífico, la riqueza en materia orgánica y el potencial de aprovechamiento como materia prima en procesos industriales. En cuanto al valor energético, puede decirse que la propiedad energética más importante es el poder calorífico, cuyo valor, para algunos residuos agropecuarios, oscila entre 2.000 y 5.000 kcal/Kg (residuos de sarmiento y residuos de pino, respectivamente) (Cabrera 2006). El valor energético varía dependiendo de la naturaleza del residuo. Por otra parte, hay que destacar el valor agrícola que poseen los residuos agropecuarios, ya que presentan elementos favorables para su incorporación al suelo agrícola, tales como:
• Riqueza en materia orgánica;
• Nutrientes (de gran interés no sólo por poseer nitrógeno, fósforo y potasio, sino también por ser ricos en oligoelementos para controlar diversos procesos fisiológicos necesarios para los cultivos);
• Abundancia de agua;
• Microorganismos necesarios para el suelo.
La economía circular se presenta como un sistema de aprovechamento de recursos que apunta a la reducción, la reutilización y el reciclaje de los residuos agropecuarios. Para lograr el aprovechamiento agrícola de los residuos, se exigen procesos de fermentación, necesarios para la obtención de un producto equilibrado con una materia orgánica estable que al llegar al suelo pueda mineralizarse y mejorar las propiedades del mismo (Bragachini 2015).
En relación al aporte al sector ganadero cabe mencionar que, tradicionalmente, los residuos de naturaleza fibrosa han sido aprovechados por la ganadería como complemento a una dieta alimenticia (pajas, residuos de huerta, residuos de frutos, etc.). En la actualidad, la ganadería consume múltiples
216 DESARROLLO SOSTENIBLE
subproductos y residuos derivados de procesos industriales (como primera elaboración de productos agrícolas) que se comercializan con el nombre de bagazos, tortas, pulpas, etc., los cuales presentan una composición química favorable. Por otra parte, la digestibilidad de estos productos por el ganado es muy reducida o casi nula.
En particular, el término “biomasa” hace referencia a la materia orgánica, ya sea de origen animal o vegetal, la cual incluye a su vez los residuos provenientes de su transformación natural o artificial. Su gran heterogeneidad en cuanto a origen, composición, recolección, tratamiento y distribución geográfica, le otorga un sello distintivo cuando es comparada con otros recursos energéticos primarios menos complejos. Es posible identificar tres tipos de biomasa:
• La biomasa natural, la cual es producida en la naturaleza, sin considerar la intervención del hombre;
• La biomasa residual, la cual es generada a partir de la actividad humana –tal como residuos domiciliarios o aguas residuales–, o bien resultante de actividades económicas provenientes del sector agrícola, ganadero, silvícolo-forestal o agroindustrial;
• La biomasa producida, que es aquella que se cultiva con el propósito de obtener combustible, como es el caso del cultivo de la caña de azúcar o del maíz para la obtención de etanol (Di Paola 2013).
La Secretaría de Energía, la Secretaría de Ambiente y Desarrollo Sustentable, la Secretaría de Agricultura, Ganadería, Pesca y Alimentación y el Instituto Nacional de Tecnología Agropecuaria (INTA), con la colaboración de otros organismos, ha realizado un estudio para evaluar la cantidad de biomasa natural de Argentina, empleando la metodología desarrollada por la FAO, denominada WISDOM (Woodfuel Integrated Supply/Demand Overview Mapping) (FAO 2003). En este estudio hubo factores clave que se tuvieron en cuenta, tales como la sostenibilidad económica, ambiental y social.
De acuerdo al informe provisto por el estudio en Junio de 2008, es posible afirmar que la cantidad de biomasa total (sumando la accesible y la potencial estimada por el modelo empleado), es mayor a 148 millones de toneladas. Por otra parte, la denominada “biomasa comercial” accesible y potencialmente disponible superó los 124 millones de toneladas. A fin de acotar el potencial disponible, la Secretaría de Energía de Argentina ha realizado un relevamiento de proyectos destinados a la generación de electricidad con biomasa, cuantificado mediante estudios de campo. Ese relevamiento indicó un potencial alrededor de 422 MW (INTI 2008). “La potencialidad de producción de bioenergía en la Argentina es de extrema importancia dada la característica de su actual matriz energética, y por las ventajas comparativas que presenta para la producción de vectores biológicos energéticos de diversas fuentes. Sin embargo, existen restricciones relacionadas tanto desde la generación de biomasa, como desde la ingeniería de procesos, ya que debería lograrse una
217 ECONOMÍA CIRCULAR
tecnología local madura de alta confiabilidad y bajo costo aplicable a diferentes escalas” (INTI 2008).
Como se expuso en párrafos anteriores, dentro de la amplia gama de residuos que se originan en las distintas actividades productivas se encuentran los residuos orgánicos agropecuarios, los cuales son generados en las explotaciones agrícolas, ganaderas o silvícolas. Generalmente, estos residuos son empleados en los mismos establecimientos en los que se producen, siendo en muchos casos materia prima que se destina a los suelos en forma de abono o a la alimentación animal.
Las producciones agropecuarias de origen animal y de carácter intensivo (tales como los feedlots1 , tambos, criaderos de aves, cerdos y conejos) dan origen a una gran cantidad de excretas diarias (biomasa) que causan impactos negativos significativos al medio ambiente si es que no se realiza un tratamiento adecuado. Según un informe publicado por la FAO en 2006, se afirma que la actividad ganadera, a través de las excretas, genera más Gases de Efecto Invernadero (GEI) que el sector de transporte, medido en su equivalente en dióxido de carbono (CO2), siendo también una de las principales causas de la degradación del suelo y de los recursos hídricos. El tratamiento del estiércol implicaría una mejora en los indicadores de productividad y rentabilidad del establecimiento agropecuario, otorgando la posibilidad de generar biogás y biofertilizantes naturales aptos para los cultivos, productos que bien podrían ser comercializados en el mercado (Cristiano 2016). Su aplicación sin el tratamiento previo es nociva a largo plazo para los suelos. Por otra parte, desde el punto de vista medioambiental, se contribuiría con una reducción sensible en la emisión de los GEI.
Según un informe publicado por la Secretaría de Ambiente y Desarrollo Sustentable de la Nación Argentina en 2015, en el país, el sector de la agricultura y la ganadería generó el 28% del total de las emisiones de gases de efecto invernadero en 2012. Durante los últimos años, la expansión de la agricultura ha opacado el crecimiento de la actividad ganadera. Esto se debió, por un lado, a los elevados precios internacionales de los granos que incentivaron el incremento de la superficie implantada y, por otro, al paulatino deterioro que enfrentaba el sector ganadero en términos de bajos precios, sequía y pérdida de stock. Esto conllevó a la reducción del número de hectáreas destinadas a la ganadería, extendiéndose la modalidad ganadera productiva de tipo intensivo, como los feedlots.
Dada esta nueva situación, los establecimientos se encontraron ante la problemática vinculada al elevado volumen de estiércol que se generaba diariamente. Muchos de ellos hallaron una alternativa válida para darles un destino a las deposiciones bovinas, la que no sólo contribuyó a solucionar el
1El feedlot es un sistema intensivo de producción de carne en donde los animales se encuentran en corrales, bajo un estricto control sanitario y nutricional (dietas de alta concentración energética y alta digestibilidad). El objetivo de esta modalidad de producción consiste en producir la mayor cantidad de carne en el menor tiempo y al menor costo posible (UNCPBA, 2008).
218 DESARROLLO SOSTENIBLE
problema de base. Mediante el tratamiento de las mismas en los biodigestores se logró disminuir los efectos negativos provocados por las emisiones de metano y dióxido de carbono al medio ambiente, como así también obtener biogás y biol que es un fertilizante sin efectos residuales. De acuerdo a la información proporcionada por el Instituto de Promoción de la Carne Vacuna Argentina (IPCVA), a partir de 2011 el número de establecimientos con feedlots ha ido en aumento (IPCVA 2009). Según el INTA, se estima que la cantidad de residuos que se generan en todas las cadenas productivas del país podría ser reutilizada para producir fertilizantes y electricidad (INTA 2014). De esta forma, los desechos se convierten en insumos estratégicos dando paso a una nueva configuración productiva que conserve el medio ambiente, en la que cobran importancia las actividades de generación de energías renovables a partir de la utilización de la biomasa. Este tipo de fuente renovable de energía está adquiriendo desde hace unos años un papel cada vez más relevante en la agenda pública del mundo y en particular de Argentina. Los factores que explican esto son, por un lado, la preocupación por aumentar la oferta interna de energía, es decir, por la seguridad energética y el autoabastecimiento, y por otro lado, la necesidad de mitigar los efectos del cambio climático, reduciendo las emisiones de GEI. En este contexto, la incorporación de la bioenergía en la matriz energética nacional adquiere especial relevancia.
Es importante mencionar que hasta Noviembre de 2016, Buenos Aires no contaba con una legislación que regulara la actividad ganadera bajo la modalidad de feedlots, siendo ésta la provincia que mayor cantidad de establecimientos hoteleros declarados posee según la Cámara Argentina de Feedlots, entendiendo por éstos a los espacios que pueden albergar animales destinados al engorde durante cierto período y por el que se cobra un determinado alquiler durante su estancia hasta que alcancen el peso pactado para su posterior venta. A ello habría que sumarle los establecimientos agropecuarios ganaderos que producen carne en forma intensiva bajo esta modalidad.
3. PROBLEMÁTICA AMBIENTAL VINCULADA A LA PRODUCCIÓN DE CARNE
La cantidad de establecimientos ganaderos que producen carne vacuna en forma intensiva ha ido en aumento en los últimos años. Esto conlleva a repensar la problemática ambiental que trae aparejada esta actividad por la gran acumulación de estiércol que genera, con el agravante de constituirse en una potencial fuente contaminante de los cursos de agua empleados fundamentalmente para el riego, más allá de los efectos negativos que impactan en el suelo y en el aire. Es de destacar que entre los elementos más contaminantes liberados por el estiércol hacia la atmósfera se destaca el amoníaco, como así también otros GEI, los cuales incluyen metano y óxido nitroso. El metano es uno de los gases de efecto invernadero más nocivo, 23 veces más potente
219 ECONOMÍA CIRCULAR
que el CO2. El estiércol contribuye con el 16 % de las emisiones globales (IPCC 2006).
Numerosos estudios indican los efectos nocivos que se producen a raíz de la intensificación de la ganadería. “(…) en Argentina se ha detectado una acumulación en suelos de más de 220 Kg/ha de nitratos, de 2500 ppm de fósforo y de 261 Kg/ha de cinc. Es frecuente que en el agua subterránea se detecte un exceso de nitratos (180 ppm) y contaminación microbiológica. De manera reciente también se registró fósforo (7 ppm) y hasta 90 ppb de cobre. En aguas superficiales, el escurrido de corrales ha incrementado los sedimentos casi 29 veces y también se registró resistencia a varios antibióticos (5 a 95% de cepas de Escherichia coli), y otros problemas emergentes como la emisión de gases de efecto invernadero (371 Kg/ha de metano)” (Herrero y Gil 2008).
El exceso de nutrientes sobre el terreno (estiércol + orina) conlleva a la eutrofización del agua, que no es más que una de las consecuencias de los procesos de contaminación provocados principalmente por los excesos de N y P. Estos nutrientes facilitan la proliferación de organismos vegetales que agotan el oxígeno del agua, provocando la ausencia de vida en ella y el posterior mal olor y su mala calidad.
El INTA afirma que en los últimos 50 años la producción mundial de carnes – bovina, porcina, aviar, caprina y ovina– aumentó un 421%, y se prevé que para el año 2050 esta tendencia continúe (INTA 2014). Desechar los residuos sin un tratamiento previo provoca la emisión de gases de efecto invernadero, la contaminación del agua y del suelo y la proliferación de plagas. “Agregarle valor a la biomasa residual para generar en principio biogás constituye una oportunidad económica, ambiental y socialmente viable por tratarse de un insumo disponible localmente” (op. cit.).
Un informe publicado conjuntamente por OCDE y FAO en 2016 postula que las perspectivas que reviste el mercado mundial de carne proyectadas hacia 2025 son favorables. Se espera una estabilización del sector cárnico, ya que “operaba con costos de alimentación particularmente elevados y volátiles en la mayor parte de la década pasada”. Asimismo, está previsto que la producción mundial de carne sea un 16% mayor en 2025, comparado con el período base de análisis 2013-2015. Es de esperar que el incremento en la producción sea liderado por los países en desarrollo, que son los que actualmente emplean la harina proteica en las raciones de forrajes (OCDE-FAO 2016).
4. CASO DE ESTUDIO
En esta parte se estudiará el caso de una región situada al sur de la provincia de Buenos Aires, de carácter agropecuario y agroindustrial, y a la cual es posible definirla como una unidad territorial, con características propias que la distinguen. La misma tiene connotaciones particulares, ya que sus posibilidades de desarrollo giran en torno a un recurso natural: las aguas del
220 DESARROLLO SOSTENIBLE
Río Colorado, las cuales permitieron el cultivo de diversas hortícolas dando paso a diversas agroindustrias. Sin embargo, cabe mencionar que de acuerdo a las fuentes primarias consultadas, esta zona, a partir de 2009, comienza a transformar el mapa productivo que la caracteriza y es en este sentido que cobra importancia la producción de carne en términos intensivos. Esto conlleva a repensar la problemática ambiental que trae aparejada esta actividad por la gran acumulación de estiércol que genera, con el agravante de constituirse en una potencial fuente contaminante de los cursos de agua empleados fundamentalmente para el riego. Es por ello que en esta parte se abordará el tema y se propondrá como una alternativa válida para las empresas agropecuarias el tratamiento de estos residuos, con posibilidades de generar productos con valor comercial.
La región del Valle Bonaerense del Río Colorado denominada también región de CORFO Río Colorado (Corporación de Fomento del Río Colorado, CORFO RC) está situada a 800 kilómetros de la ciudad de Buenos Aires y posee una población total cercana a los 35.000 habitantes. Es una de las cuencas hídricas más importantes que tiene el país.
El Valle Bonaerense del Río Colorado tiene un clima semiárido templado, con una temperatura media anual de 15°C. El promedio de lluvias es de 400 mm anuales. Estas no son uniformes durante el año, ya que se concentran principalmente entre los meses de abril y junio, por un lado, y septiembre y diciembre, por el otro. Ello conduce a un importante déficit hídrico que oscila entre los 300 y 500 mm anuales; de allí la importancia que reviste contar con un adecuado sistema de riego, ya que algunas producciones dependen en su totalidad del mismo (Iurman 2009). El valle presenta suelos muy variados con predominio de los suelos arenosos, que permiten el desarrollo de una amplia gama de cultivos (trigo, maíz, girasol, sorgo, alfalfa, trébol, cebolla, ajo y papa), todavía requiriendo un buen sistema de drenaje para evitar los problemas de salinidad.
En la región se localiza una gran cantidad de productores que, en general, presentan una pequeña y mediana escala, siendo el estrato que abarca el rango 10-100 ha el que incluye el mayor número de establecimientos. La mayoría de ellos basa su actividad en el cultivo de la cebolla (cuyo principal destino es la exportación), de la cual obtienen la mayor parte de sus ingresos (Iurman, 2010). A partir de esta base se incluye una amplia diversidad de otras producciones que enriquecen el sistema productivo, desarrollándose cultivos de carácter intensivo y extensivo, tales como girasol, semillas de alfalfa y zapallo, entre otros. Por otra parte, también es posible encontrar establecimientos de producción intensiva de carne aviar, de cerdo, de conejo y de carne vacuna, los cuales generan una gran cantidad de residuos orgánicos.
En cuanto al sector ganadero, de acuerdo a los datos proporcionados por la estación experimental del INTA de dicha zona, el número de cabezas de ganado que se encuentra bajo la modalidad productiva en encierre (feedlot)
221 ECONOMÍA CIRCULAR
en la región de Corfo Río Colorado ascendía a 30.750 en 2017. A partir de aquí es posible calcular la cantidad de efluentes generados y el potencial que estos tienen en términos de ser transformados en biofertilizantes mediante la técnica de compostaje2 para luego ser aplicados en los propios establecimientos o bien comercializados en el mercado.
Considerando algunas cuestiones biológicas y parámetros técnicos, según Pordomingo (2014), teniendo en cuenta la digestibilidad de la dieta del vacuno, un novillo de 450 Kg produce un promedio diario de 27 Kg de excrementos húmedos (orina y heces), con una variación de 25% (dependiendo del clima, el consumo de agua y el tipo de dieta). Esto implica que en la zona se están generando diariamente 830.250 Kg de excrementos, los que totalizan 24.907,5 t mensuales.
Bragachini et al. (2015) estima que este estiércol posee un 20% de materia seca, lo que equivaldría a 81 t de materia seca al mes en la región. De acuerdo a la literatura consultada, existen diferencias entre las diferentes proporciones de nutrientes por t de materia seca. Siguiendo a Pordomingo (2014) una tonelada de excrementos de bovinos (orina más heces) contiene en promedio 5 Kg de Nitrógeno (N), 1 Kg de Fósforo (P) y 4 Kg de Potasio (K). Si no se considera la fracción líquida, el excremento resulta en 2,5 Kg de Nitrógeno, 1 Kg de Fósforo y 0,8 Kg de Potasio.
A partir de lo anteriormente descripto, es posible estimar la cantidad de nutrientes que puede obtenerse en la región (Tabla 1), la cual asciende a 256,92 t/año (Cristiano 2018):
Tabla 1. Potencial cantidad de nutrientes a obtener en la región.
Algunos de los fertilizantes comerciales más comúnmente empleados para la reposición de nutrientes son: Urea, cuyo componente principal es el N (46%), Fosfato Diamónico (16% de P) y Cloruro de Potasio (60% de K). Los precios por tonelada se exponen en la Tabla 2:
2La técnica de compostaje es una biotécnica donde es posible ejercer un control sobre los procesos de biodegradación de la materia orgánica a los efectos de que el producto final (el compost, que es un biofertilizante o fertilizante orgánico) esté disponible y en forma óptima tanto para el cultivo como para el suelo.
222 DESARROLLO SOSTENIBLE
Nutrientes t/mes t/año N 12,45 149,4 P 4,98 59,76 K 3,98 47,76 Total 21,41 256,92
Tabla 2. Precios por tonelada de fertilizantes comerciales y sus nutrientes correspondientes.
En base a la cantidad de estiércol producida en la zona, es posible estimar los potenciales ingresos por ventas (Valor Bruto de Producción) que percibiría la región suponiendo el tratamiento de las 4.981,5 t de materia seca obtenidas a partir del estiércol generado por 30.750 cabezas, los cuales ascienden a US$ 349.838,12 (Cristiano 2018), tal como puede apreciarse en la Tabla 3. Es importante destacar que, más allá de estos valores, la zona se vería favorecida por la dinámica regional que esta actividad traería aparejada en términos de generación de empleo vinculada directamente al tratamiento del residuo y envasado, como así también en materia de transporte y logística.
Tabla 3. Potenciales ingresos totales por venta de estiércol que generaría la región.
Otra alternativa que podría considerarse es la producción de energía a partir del tratamiento de los efluentes bovinos (estiércol más heces) en biodigestores (INTA 2015). Los biodigestores o reactores anaeróbicos son instalaciones dentro de las cuales se lleva a cabo un proceso de digestión anaeróbica con bacterias específicas. El residuo final del proceso, denominado biol, es un biofertilizante líquido, apto para aplicar directamente al suelo. De acuerdo a estudios realizados (Pordomingo 2014), por cada tonelada de estiércol fresco bovino es posible obtener en promedio 25 m3 de biogás. A su vez, 1 m3 de biogás equivale a 5.000 Kcal, lo cual representa aproximadamente 1,6 KWh de electricidad. Cabe destacar que, si bien 1 m3 de biogás equivale a 6,06 KWh, así, la eficiencia se ve afectada al convertirla (de allí su menor rendimiento).
223 ECONOMÍA CIRCULAR
Fertilizante Nutriente (en %) uS$ /t urea 46% N 410 Fosfato diamónico 16% P 495 Cloruro de potasio 60% K 400
Nutriente t/año Ingreso total anual (en uS$) N 149,4 133.115,4 P 59,76 184.882,5 K 47,76 31.840,2 Total 256,92 349.838,12
En la región, la disposición de 24.907,5 t de biomasa residual proveniente de la actividad ganadera generarían 622.687,5 m3 mensuales de biogás (996.300 KW, o lo que es su equivalente, 996,3 MW). Las políticas de promoción prevén un precio de 160 US$ por cada MW generado a partir de biomasa (según lo establecido en el plan RenovAr Ronda I de fomento a las energías renovables). En este caso, en base a un cálculo estimativo, los potenciales ingresos mensuales de la región provenientes de la venta de energía eléctrica ascenderían a US$ 159.360,00 lo que en términos anuales sería US$ 1.912.320,00.
CONSIDErACIONES FINALES
La problemática medioambiental es un tema prioritario a nivel mundial en la agenda del sector público y, en algunos casos puntuales, en la del sector privado. Por tal razón, las políticas públicas implementadas en los últimos años en la República Argentina han tendido a promocionar, entre otros, el tratamiento de desechos orgánicos. El perfil agropecuario y agroindustrial del país hacen factible este hecho, dado que cuenta con un volumen potencial de residuos a ser tratados.
El objetivo principal de este trabajo fue mostrar una alternativa para valorizar los residuos orgánicos provenientes del sector productor de carne vacuna en una región situada al sur de la provincia de Buenos Aires, la que se encuentra en una de las cuencas hídricas más importantes de Argentina. Para ello, se propuso reconvertir a los establecimientos productores de carne vacuna, pasando de un proceso monoproductivo a uno multiproductivo.
Este estudio muestra que es posible que las distintas firmas agroalimentarias incrementen su rentabilidad, ya que podrán comercializar no sólo carne sino también biofertilizante, disminuyendo así también los efectos negativos que este tipo de actividad productiva ocasiona al medioambiente.
REFERêNCIAS BIBLIOGRÁFICAS
Aguilera Klink F, Alcántara V (2011) De la economía ambiental a la economía ecológica. CIP-Ecosocial. Barcelona, pp.5- 408. Bragachini M et al. (2015) Oportunidades de la bioenergía en el sector agropecuario: efluentes y cultivos energéticos. http://inta.gob.ar/documentos/oportunidades-de-la-bioenergia-en-el-sector-agropecuario-efluentes-y-cultivos-energeticos. Acceso noviembre de 2015. Cabrera S et al. (2006) Biocombustibles a partir de residuos lignocelulósicos. Estudio económico del caso: bagazo de caña en México. http://www.smbb. com.mx/congresos%20smbb/puertovallarta03/TRABAJOS/AREA_XIII/CARTEL/CXIII-2.pdf. Acceso septiembre de 2015. Cristiano G (2016) Tratamiento de los residuos orgánicos agropecuarios y generación de biogás en Argentina. En: Guzowski C et al. Los Desafíos de la política energética argentina. Buenos Aires, 150-120.
224 DESARROLLO SOSTENIBLE
Cristiano G (2018) Proyecto de desarrollo regional: un modelo basado en el tratamiento de residuos orgánicos agropecuarios. El caso de la zona de CORFO-Río Colorado. Tesis doctoral. Dpto. de Economía. Universidad Nacional del Sur. http://repositoriodigital.uns.edu.ar/handle/123456789/4409. Acceso agosto de 2016.
Di Paola M (2013) La producción de biocombustibles en Argentina. https:// www.google.com.ar/#q=la+produccion+de+biocombustibles+en+argentina. Acceso agosto de 2016.
Eskeland G y Jiménez E (1992) Policy instruments for pollution control in developing countries. The World Bank Research Observer, 7(2):145-169.
FAO (2003) Metodología aplicada en el análisis de recursos biomásicos y de residuos para uso combustible. http://www.fao.org/docrep/013/i1708s/ i1708s07.pdf. Acceso febrero de 2017.
Flotats X (2010) Biogás y gestión de deyecciones ganaderas. En SUIS/IVIS, (72), 22-29.
Herrero MA y Gil SB (2008) Consideraciones ambientales de la intensificación en producción animal. Producción animal intensiva y medio ambiente. Ecología austral. Asociación Argentina de Ecología, 273-289.
INTA. Instituto Nacional de Tecnología Agropecuaria (2014) El tratamiento de los residuos, clave en la gestión ambiental. http://intainforma.inta.gov. ar/?p=24508. Acceso febrero de 2016.
INTA. Instituto Nacional de Tecnología Agropecuaria (2015) Bioenergía: innovar a partir de los residuos. http://intainforma.inta.gov.ar/?p=28974. Acceso febrero de 2016.
INTI. Instituto Nacional de Tecnología Industrial (2008) Matriz de oferta y demanda de bioenergía. Situación actual y desarrollo potencial en Argentina. Taller de Bioenergía, CA de Bs. As. http://www.inti.gob.ar/e-renova/erTO/ pdf/TallerBioenergia.pdf. Acceso febrero de 2017.
IPCC. International Panel of Global Change (2006) Guidelines for national greenhouse gas inventories. In: Eggleston H et al. (Eds.) The National Greenhouse Gas Inventories Programme. Intergovernmental Panel on Climate Change IGES. Hayama, Kanagawa, Japan, 3-20.
IPCVA. Instituto para la Promoción de la Carne Vacuna Argentina (2009) Estructura del feedlot en Argentina. Nivel de asociación entre la producción bovina a corral y los titulares de faena. http://www.ipcva.com.ar/files/Trabajo%20integracion%20feedlot.pdf. Acceso agosto de 2016.
Iurman D (2009) Sistemas agropecuarios representativos de Villarino y Patagones. Análisis y propuestas. Actualización Enero 2009. Proyecto Regional “Diagnóstico y prospectivas socioeconómicas de sistemas y cadenas productivas del área del CERBAS para el fortalecimiento de la capacidad de gestión regional”. Ed. INTA EEA Hilario Ascasubi, 93p. Iurman D (2010) Sistemas agropecuarios representativos de Villarino y Patagones. Análisis y propuestas. Actualización Diciembre 2010. Ed. INTA EEA Hilario Ascasubi, 1-34.
Martínez AN y Porcelli AM (2018) El desafío del cambio económico: la economía circular y su excepción en las diferentes legislaciones y en la normativa voluntaria. Pensar en Derecho, 13:129-181.
225 ECONOMÍA CIRCULAR
OCDE-FAO (2016) Perspectivas agrícolas 2016-2025. Enfoque especial: Africa subsahariana. OECD Publishing, París doi:10.1787/agr_outlook-2016-e. http://www.fao.org/3/a-i5778s.pdf.
Pordomingo A (2014) Efectos ambientales de la intensificación ganadera. Ed. Instituto Nacional de Tecnología Agropecuaria- INTA Anguil. La Pampa, 34p. UNCPBA. Universidad Nacional del Centro de La Provincia de Buenos Aires (2018) Evaluación, diagnóstico y propuestas de acción para la mejora de las problemáticas ambientales y mitigación de gases de efecto invernadero vinculados a la producción porcina, avícola y bovina (feedlots y tambos). Estudio de Performance Ambiental desarrollado para el Fondo Argentino del Carbono. Contrato UNCPBA-Banco Mundial Nº 7145486, 245p.
226 DESARROLLO SOSTENIBLE
U
TILIZACIÓN
DE R ESIDUOS DE LA INDUSTRIA AGROALIMENTARIA PARA EL DESARROLLO DE BIOMATERIALES
Agustín González & Cecilia I. Alvarez Igarzabal
Universidad Nacional de Córdoba (UNC), Facultad de Ciencias Químicas, Departamento de Química Orgánica. Instituto de Investigación y Desarrollo en Ingeniería de Procesos y Química Aplicada (IPQA-CONICET), Medina Allende y Haya de la Torre, Ciudad Universitaria, Córdoba, Argentina. E-mail: agustingonzalez@unc.edu.ar
INTRODUCCIÓN
En los últimos 50 años, la demanda de los productos plásticos convencionales derivados del petróleo ha crecido exponencialmente debido a que los mismos proporcionan el balance necesario de propiedades que no pueden lograrse con otros materiales. Su uso es masivo a nivel mundial, siendo la industria de envases y empaques el principal destino de estos materiales con un 39,7% del volumen (donde el 45,5% es empleado para envases de alimentos), seguido de lejos por productos de consumo, textil, sector eléctrico, transporte, maquinaria industrial y construcción (Grupo de Estudios de Mercado de PlasticsEurope (PEMRG) y Conversio Market and Strategy GmbH 2017).
Se estima que hasta fines de 2019 se han producido 8.300 millones de toneladas de plásticos vírgenes en el mundo, del cual el 9% se ha reciclado, el 12% se ha incinerado y el 79% se encuentra acumulado en vertederos o entornos naturales. Si se sigue con esta tendencia, en 2050 habrá aproximadamente 12.000 millones de toneladas de plásticos acumuladas en el medio ambiente (Geyer et al. 2017). La gran acumulación de este material, que tarda entre 50 y 600 años en degradarse (según su naturaleza y ambiente) produce problemas de contaminación ambiental de escalas magníficas, que afectan seriamente la calidad de vida de las personas, así como también la salud del ecosistema.
Debido a esta situación, es que en la actualidad y desde hace unos años, la sociedad, la industria y la comunidad científica se encuentran propiciando investigaciones capaces de desarrollar materiales biodegradables que sean capaces de reemplazar en forma total o parcial a los plásticos convencionales para usos en recubrimientos, envoltorios (empaques), agricultura (par recubrimiento de cultivos, granos y semillas), medicina y otras áreas.
Stadnik MJ, Velho AC, Zorrilla SE (eds.) Desarrollo Sostenible en la Producción Agroalimentaria
227
14
1. POLÍMEROS BIODEGRADABLES: CONCEPTO y CLASIFICACIÓN
La American Society of Testing and Materials (ASTM Standard D5988 2012) define un material biodegradable como “aquel capaz de descomponerse en CO2, metano, agua, componentes inorgánicos o biomasa, mediante la acción enzimática de microorganismos que puede ser medida por ensayos estandarizados en un período específico, en condiciones normalizadas de depósito. De acuerdo a su origen, los polímeros biodegradables se pueden clasificar en las siguientes categorías:
• Polímeros extraídos directamente de fuentes naturales, fácilmente disponibles a través de fuentes renovables;
• Polímeros producidos por síntesis química clásica, a partir de monómeros biológicos renovables, citando como el mejor ejemplo al poli (ácido láctico);
• Polímeros producidos por microorganismos o bacterias.
Los polímeros categorizados en el primer grupo, presentan importantes ventajas frente a los restantes. Una de las principales, es que pueden ser extraídos de fuentes vegetales o animales (renovables) y particularmente de residuos o subproductos que su industrialización genere. Por lo tanto, generalmente es de bajo costo (González 2013).
Recientemente se encuentra en gran desarrollo el aislado de compuestos formadores de biomateriales a partir de los desechos generados en las industrias de procesamiento de alimentos. Las grandes cantidades de desperdicio de alimentos (cáscaras, semillas, forrajería, restos de alimentos) producen serios problemas de manejo desde el punto de vista económico y ambiental. Para superar esta situación, se han desarrollado conceptos de ecología industrial, con el objetivo de utilizar los desechos industriales como materias primas para nuevos productos y aplicaciones (Etxabide et al. 2017)
2. UTILIZACIÓN DE SUBPRODUCTOS O RESIDUOS DE INDUSTRIAS AGROALIMENTARIAS
Resulta muy notable que la gran mayoría de los componentes naturales capaces de formar biomateriales puede ser extraídos de subproductos o residuos de industrias agroalimentarias, lo cual, por un lado, ofrecen un importante valor agregado a estos componentes que, por su condición de ser desechos, tienen muy bajo valor económico. Por el otro, brindan numerosos beneficios para el medioambiente, aportando significativamente al desarrollo sostenible de dichas cadenas agroalimentarias.
De acuerdo con un nuevo estudio publicado por la Comisión Económica para América Latina y el Caribe (CEPAL) perteneciente a las Naciones Unidas, una bioeconomía es una economía basada en el consumo y la producción de
228 Desarrollo sostenible
bienes y servicios derivados del uso directo y la transformación sostenibles de recursos biológicos, incluyendo los desechos de biomasa generados en los procesos de modificación, producción y consumo, aprovechando el conocimiento de los sistemas, principios y procesos, y las tecnologías aplicables al conocimiento y transformación de los recursos biológicos y a la emulación de procesos y principios biológicos (Rodríguez et al. 2017). Este informe menciona tres conceptos claves que deben servir de base para el desarrollo de estrategias nacionales y regionales de bioeconomía: la biodiversidad, la capacidad para producir biomasa para diversos usos, y la disponibilidad de subproductos y desechos agrícolas y agroindustriales. Este último punto resulta trascendental para lograr un desarrollo sostenible de las industrias agroalimentarias. La bioeconomía representa un concepto en auge en la actualidad que nos brinda alternativas para la utilización inteligente de los territorios, para la innovación con enfoque de sostenibilidad, así como también para potenciar políticas de desarrollo de las áreas agrícolas, rurales y alimentarias, poniendo especial énfasis en la optimización de los recursos (en especial si se menciona recursos tan valiosos como los derivados de alimentos) y en la protección del medio ambiente. Por todo esto, la utilización de los subproductos y residuos obtenidos a partir del procesamiento de alimentos derivados de la agroindustria resulta un desafío muy importante en la actualidad. Como se mencionó anteriormente, numerosas investigaciones tendientes a la utilización de derivados agroalimentarios, en particular para la preparación de materiales biodegradables para ser usados como recubrimiento de alimentos se encuentran documentadas en diversas publicaciones nacionales e internacionales. Entre ellos, los más estudiados son los derivados de materiales proteicos y de polisacáridos. Para todos ellos, el mecanismo de estudio se puede resumir en la Figura 1.
3. UTILIZACIÓN DE PROTEÍNAS y POLISACÁRIDOS COMO PELÍCULAS BIODEGrADABLES
Las propiedades químicas de las proteínas alimentarias dependen de las cantidades relativas de residuos de aminoácidos presentes y de su posición a lo largo de la cadena proteica. Un gran número de proteínas de distinto origen han sido estudiadas por su capacidad de formar películas comestibles y/o biodegradables. Las proteínas de origen animal más estudiadas son las caseínas, las proteínas de suero de leche, el colágeno y la gelatina, mientras que las de origen vegetal son las proteínas de soja y girasol.
Las biopelículas, se forman a escala de laboratorio generalmente a partir de la metodología de “casting” donde soluciones o dispersiones de proteínas son evaporadas formándose la película en el fondo del envase (González 2013). Las cadenas proteicas pueden asociarse a través de enlaces puentes
229 Desarrollo D e Biomateriales
hidrógeno, enlaces iónicos, hidrofóbicos y covalentes y reaccionar con agentes entrecruzantes adecuados (González et al. 2011), formar injertos (González y Alvarez Igarzabal 2017) o sufrir otras modificaciones químicas. Los polímeros que contienen grupos que se pueden asociar a través de interacciones puente hidrógeno o iónicas, forman películas que son excelentes barreras al oxígeno, pero son susceptibles a la humedad (Bourtoom 2008), por lo que se espera que las películas proteicas sean buenas barreras al oxígeno a bajas humedades relativas.

Figura 1. Mecanismo de estudio para el desarrollo de materiales de recubrimiento biodegradable/comestible de alimentos a partir de residuos de la industria agroalimenticia.
3.1 Proteínas de soja
Las proteínas vegetales se encuentran disponibles en gran cantidad, siendo el subproducto de la producción de aceite de soja de mayor volumen. Dentro de la producción de oleaginosas realizada en la Argentina, la de soja es la que reviste mayor importancia llegándose a procesar 152.000 toneladas de soja por día para la producción de aceite. Aproximadamente el 50% del aceite producido en el mundo es de soja (Puppo et al. 2007).
De acuerdo a la normativa vigente en Argentina (Secretaría de Agricultura Ganadería Pesca y Alimentos 1999) se entiende por subproductos oleaginosos, a los “residuos sólidos resultantes de la extracción industrial del aceite de granos oleaginosos, obtenidos por presión y/o disolvente, provenientes de la elaboración de mercadería normal, sin el agregado de cuerpos extraños ni aglutinante”. Dentro de los subproductos comercializados, existen componen-
230 Desarrollo sostenible
tes de alto interés para la industria alimentaria. En primer lugar, las proteínas constituyen alrededor del 44% de las harinas de soja (Puppo et al. 2007). El uso de proteínas de soja en la formación de biopelículas o recubrimientos se encuentra extensamente investigado (González et al. 2011, González y Alvarez Igarzabal 2013, 2015, 2017, González et al. 2019, Koshy et al. 2015, Tang 2019, Tian et al. 2018) debido a que la utilización de proteínas de soja ha mostrado ventajas frente a los materiales extraídos de otras fuentes renovables debido a su excelente habilidad para formar films, buenas propiedades de barrera al oxígeno, lípidos y aromas bajo condiciones de baja o intermedia humedad ambiente (Gennadios et al. 1993). Por otro lado, las proteínas de soja contienen 58% de aminoácidos de características polares que le dan el carácter hidrofílico a la matriz. Esta propiedad le confiere fragilidad en estado húmedo, pobres propiedades de barrera al vapor de agua y propiedades mecánicas insuficientes para ciertas aplicaciones de las películas formadas en base a esta matriz (Choi et al. 2003). Estas desventajas en el material son las que lo imposibilita de ser utilizado en diversas aplicaciones, por ejemplo, como material de recubrimiento. En general, este inconveniente se presenta en la mayoría de los biopolímeros utilizados para este fin. Diversas metodologías sintéticas, de preparación o modificación de estos recursos naturales han sido desarrolladas en los últimos tiempos por la comunidad científica, en busca de materiales con propiedades macroscópicas optimizadas capaces de reemplazar a los plásticos convencionales derivados del petróleo. Algunos tratamientos que se pueden realizar sobre estas proteínas consisten en modificarlas químicamente para formar redes tridimensionales utilizando agentes entrecruzantes. En la literatura se encuentran numerosos reportes que utilizan agentes entrecruzantes de probada eficacia, mediante los cuales se obtienen películas con propiedades mecánicas optimizadas y mayor resistencia a la humedad, como es el caso de la utilización de glutaraldehído (Park et al. 2000), formaldehido (Marquié 2001) o glioxal (Vaz 2005), sin embargo, desde el punto de vista de la sustentabilidad, estos componentes no son adecuados por presentar elevada citotoxicidad. Por esto, se busca la utilización de agentes entrecruzantes no tóxicos para el desarrollo de biomateriales con potenciales aplicaciones como recubrimiento de alimentos y/o dispositivos de liberación controlada de fármacos en usos medicinales. Así, se estudió el entrecruzamiento de proteínas de soja con genipina, producto natural 10.000 veces menos citotóxico que el glutaraldehído, para la preparación de películas (Fig. 2), utilizando glicerol como plastificante (Song y Zhang 2009). En este estudio, la eficiencia de la reacción de entrecruzamiento fue evidenciada por FTIR (espectrometría infrarroja con transformada de Fourier) y por la determinación de grupos amino libres en ausencia y presencia del entrecruzante. La genipina tiene el potencial para mejorar las propiedades de la película proteica, principalmente la sustancial disminución de la solubilidad, el hinchamiento en agua y su permeabilidad al vapor
231 Desarrollo D e Biomateriales
de agua. Además, se mejoraron las propiedades mecánicas con pequeñas cantidades de entrecruzante agregado, con marcados aumentos de la resistencia a la tracción. Por otro lado, se estudió su biodegradación por enterramiento en suelo y se demostró que estos tiempos pueden ser controlados o modificados desde al menos 14 a 33 días (González y Alvarez Igarzabal 2011).

Figura 2. Aspecto macroscópico de películas enterradas en suelo por diferentes períodos de tiempo. Columnas hacia la derecha representan muestras con mayor grado de entrecruzamiento (mayor intensidad de coloración) y filas hacia abajo días de enterramiento.
A su vez, estas películas pueden ser utilizadas como recubrimiento activo de alimentos, mediante el agregado de agentes antimicrobianos como es el caso del timol (antibacteriano, extraído de plantas aromáticas como el tomillo (Thymus vulgaris) o el orégano (Origanum majorana) o antifúngicos ampliamente utilizados en la industria alimenticia como la natamicina.
La incorporación de bajas cantidades de estos componentes mostró resultados positivos en la inhibición del crecimiento de mohos (Aspergillus sp), levaduras (Saccharomyces. cerevisiae) y dos cepas de bacterias, Gram+ y Gram- (Escherichia coli ATCC 25922 y Staphylococcus aureus ATCC 25923) en un ensayo microbiológico in vitro (Fig. 3).
232 Desarrollo sostenible
Película SPI-PLA
60/40% com Timol

Película SPI-PLA
60/40% com Natamicina
Figura 3. Resultados de ensayos microbiológicos de inhibición del crecimiento de mohos, levaduras y bacterias. Letra C significa muestras control (sin agente activo).
A su vez, se verificó también el aumento de vida útil de alimentos envasados en estas películas (manzana, tomate y queso) respecto a envases plásticos tradicionales (González y Alvarez Igarzabal 2013).
La aplicación de estas películas entrecruzadas en medicina, se realizó mediante la incorporación de un medicamento hipotensor ampliamente utilizado para el tratamiento de glaucoma (timolol maleato) y se estudió la efectividad de estas películas en sistemas oftalmológicos. Se observó que la liberación del fármaco puede ser modificada de acuerdo a la cantidad de entrecruzante empleado. Mediante pruebas de determinación de la presión intraocular (PIO) en conejos, se demostró que estos sistemas son muy aptos para el tratamiento de enfermedades oculares como glaucoma (González et al. 2015).
Otra modificación química realizada, consistió en llevar a cabo reacciones de injerto con monómeros vinílicos, con el fin de aportar mayor hidrofobicidad a los materiales y mejorar la susceptibilidad a la humedad. González y Alvarez Igarzabal (2017) lograron la preparación de películas por compresión con temperatura, de proteínas de soja injertadas con metacrilato de metilo. Estas películas mostraron un aumento en su carácter hidrofóbico en comparación con las películas no modificadas, ya que se lograron reducciones notables en la permeabilidad al vapor de agua, hinchamiento y solubilidad en agua y aumento en el ángulo de contacto.
Otra estrategia estudiada sobre películas de proteínas de soja consiste en la mezcla con aditivos hidrofóbicos (como aceites, ácidos grasos o ceras). Se han estudiado mezclas con aceites de coco o lino con el fin de obtener películas con buenas propiedades de barrera, específicamente para el envasado de acei-
233 Desarrollo D e Biomateriales
Aspergilllus
sp.
S. cerevisae
E.
colli S. aureus
te de oliva, mostrando disminuciones muy marcadas en las determinaciones de sus propiedades de barrera e hinchamiento y solubilidad en agua (Carpiné et al. 2015). Resultados similares se han reportado mediante el uso de ceras naturales (Gomes dos Santos et al. 2017). A su vez, también se han estudiado sistemas bicapa donde una capa formada por la proteína de soja es la que mantiene la carga de compuestos activos, mientras que la otra puede estar compuesta por otro polímero de características hidrofóbicas como el poli (ácido láctico) (SPI-PLA) (Fig. 4) (González y Alvarez Igarzabal 2013), o mediante el reforzamiento de las mismas con nanofibras de celulosa obtenidas de residuos de la soja como son las cascarillas o las vainas del poroto de soja (González et al. 2019) o nanocristales obtenidos a partir de almidón de papa (González y Alvarez Igarzabal 2015).


Figura 4. Estudio cualitativo de inhibición del crecimiento de mohos en trozos de tomates y manzanas por la utilización películas plásticas comerciales y películas bicapa SPI-PLA sin agente antimicrobiano y conteniendo Natamicina o timol.
También existen reportes de tratamientos físicos tales como cambios en las condiciones de secado y evaporación del solvente (Denavi et al. 2009) y tratamientos enzimáticos mediante la utilización de lacasas, tirosinasas y peroxidasas (Isaschar-Ovdat y Fishman 2018) o transglutaminasas (Sabbah et al. 2019). En estos casos se reportaron efectos físico-químicos producidos por el entrecruzamiento de las cadenas proteicas.
234
Desarrollo sostenible
3.2
Gelatina
La gelatina, puede ser obtenida por la hidrólisis controlada del colágeno presente en los huesos, piel y tejido conectivo generado a partir del procesamiento de animales terrestres y marinos. La gelatina de pescado ha atraído mucha atención como alternativa a las gelatinas de mamíferos debido a restricciones religiosas y al creciente desarrollo de la encefalopatía espongiforme bovina (Etxabide et al. 2017).
Siendo la gelatina un polímero derivado del colágeno y por ende biodegradable, biocompatible y no citotóxico, es adecuado y muy utilizado para aplicaciones biomédicas como soporte para la reconstrucción de tejidos, dispositivos de liberación controlada de fármacos, etc. Este material posee buenas propiedades de formación de películas o films, por lo que también se la incluye entre las proteínas con capacidades para el diseño de biomateriales (Martucci et al. 2006).
Un ejemplo de su utilización para la liberación de fármacos es el reportado por García Schejtman et al. (2015). Ellos reportaron la preparación de nuevas películas de gelatina mediante el método de casting en frío, usando cerio (III) y genipina como agentes entrecruzantes tras lo cual, su superficie fue modificada con moléculas dendríticas. Los resultados mostraron que el entrecruzamiento mejoró las propiedades mecánicas y microbiológicas de las películas de gelatina, y que se logró menor carácter hidrofílico. La metodología experimental permitió la modificación de la superficie, lográndose un nuevo biomaterial en forma de película con buenas propiedades y con la estructura dendrítica en una sola de las caras, según estudios de ATR-FTIR. Esto le confiere al film dos superficies con propiedades y comportamiento diferentes, lo que podría ser útil en aplicaciones como material biomédico.
A su vez, numerosos biomateriales han sido desarrollados para su utilización como recubrimiento comestible de alimentos. Entre ellos se pueden enumerar recubrimientos con características antioxidantes, antimicrobianas o con capacidad de microencapsular agentes activos (Etxabide et al. 2017). A su vez, estos envases activos han sido ensayados sobre alimentos como frutas y vegetales, carnes bovinas o avícolas, pescado, alimentos grasos (aceites), frutos secos, etc., mostrando en general buenos resultados en cuanto a los incrementos en sus tiempos de vida útil (Tongdeesoontorn y Rawdkuen 2019).
3.3
Caseína
La caseína representa, cuantitativamente, la fracción proteica existente en la leche bovina y se obtiene a partir del cuajo resultante de la industria láctea. Grandes volúmenes de suero lácteo se producen como subproducto de esta cadena de valor siendo la caseína uno de sus principales componentes. La caseína está compuesta principalmente por aminoácidos polares, presentando elevada hidrofilicidad. Además, presenta excelente biocompatibilidad y biodegradabilidad, lo que resulta un gran atractivo para el desarrollo
235 Desarrollo D e Biomateriales
de nuevos biomateriales farmacéuticos de uso medicinal (Picchio et al. 2018a). La propiedad intrínseca que posee la caseína para formar micelas en solución acuosa en presencia de iones Ca2+, puede ser aprovechada para la formación de nano vehículos para el transporte de fármacos hidrofóbicos hacia tejidos tumorales, para su posterior liberación de manera controlada (Wei et al. 2017).
Respecto a esto, se ha reportado la preparación de nuevos tipos de nano transportadores biodegradables a partir de micelas de caseína utilizando gliceraldehído como entrecruzante. Se corroboró que las micelas de caseína altamente reticuladas (CCM) podrían degradarse fácilmente en presencia de proteasas y pH 5 (condiciones intracelulares) pero mantienen su estructura a pH 7,4 (condiciones de plasma), mostrando de esta forma una liberación selectiva en condiciones intracelulares. Los nano vehículos preparados mostraron buena biocompatibilidad y biodegradabilidad, estabilidad en condiciones fisiológicas y rápida liberación del fármaco en respuesta al nivel intracelular de pH y degradación enzimática. Estas propiedades de las CCM las convierten en candidatos prometedores para la liberación activada (triggered) de fármacos (Picchio et al. 2018a).
A su vez, también se encuentra reportada la preparación de películas de recubrimiento a base de caseína altamente metacrilada como un macro entrecruzante. El comportamiento mecánico de las películas basadas en caseína podría ajustarse fácilmente controlando el grado de metacrilación del reticulante. Las películas preparadas mostraron hinchamiento dependiente del pH. El comportamiento de liberación de las películas basadas en caseína sugiere que estos materiales tienen un alto potencial como recubrimientos entéricos para la administración intestinal de fármacos (Picchio et al. 2018b). Por otro lado, proteínas naturales como la caseína, también son buenas candidatas para producir películas de envasado de alimentos debido a sus excelentes propiedades funcionales.
Picchio et al. (2018c) exploraron el uso de ácido tánico (AT), compuesto fenólico derivado de plantas, como agente entrecruzante para la producción de películas de caseína. Se estudió la influencia de la concentración del agente de reticulación en las propiedades mecánicas y viscoelásticas, la estabilidad térmica, el comportamiento de hinchamiento, la permeabilidad al vapor de agua, la citotoxicidad y la degradación en las condiciones de compostaje. Los resultados mostraron que el AT resultó eficaz para el entrecruzamiento de la caseína; las películas exhibieron propiedades fisicoquímicas mejoradas.
3.4 Quitosano
Los desechos marinos resultantes de las industrias de procesamiento han aumentado su volumen significativamente en los últimos años. La producción de estos coproductos marinos, sin el desarrollo paralelo de procesos de recuperación relevantes, conduce a la degradación ambiental y causa graves problemas de contaminación. Cada año se producen varios millones de tone-
236
Desarrollo sostenible
ladas de derivados pesqueros en el mundo, donde se estima que entre el 45 al 55% se destinará a material de desecho. Estos residuos son muy nocivos para el medio ambiente debido a su alta demanda biológica y química de oxígeno, patógenos y materias orgánicas, etc.
La quitina es el segundo polímero natural más abundante de la naturaleza y puede ser extraída del caparazón de crustáceos (El Knidri et al. 2018). A partir de la desacetilación parcial de este subproducto se obtiene el quitosano. Este biopolímero, posee una serie de propiedades funcionales (biocompatibilidad, biodegradabilidad, actividad antimicrobiana, capacidad para formar películas protectoras y actividad antioxidante), que lo hacen técnica y fisiológicamente útil para una amplia variedad de aplicaciones biomédicas en la administración de fármacos, curación de heridas, ingeniería de tejidos y en el área de la nanobiotecnología. La propiedad mucoadhesiva de la quitina y el quitosano proporciona un contacto íntimo con la membrana mucosa y un tiempo de residencia prolongado de los polímeros en el sitio de absorción, reduciendo así la degradación del fármaco (Dhanasekaran et al. 2018). El quitosano, conocido por su comportamiento altamente hinchable, mucoadhesivo y antimicrobiano, se usa ampliamente en aplicaciones biomédicas. Los hidrogeles de quitosano exhiben resistencia mecánica relativamente baja y capacidad limitada para controlar la liberación de compuestos encapsulados, por lo que requieren modificaciones químicas a través de sus grupos funcionales. Así, los hidrogeles de quitosano modificados han ganado importancia en la investigación actual sobre sistemas de administración de fármacos e ingeniería de tejidos. A modo de ejemplo, para liberación de curcumina, conocida por sus funciones antitumorales, antioxidantes, antiartritis, neuroprotectoras y antiinflamatorias (Saheb et al. 2019). Otros autores reportaron alta eficiencia de carga de curcumina patrones de liberación sostenidos durante un período de 80 h con liberación inicial de tipo burst. El hidrogel cargado de curcumina mostró una actividad antibacteriana leve contra Proteus mirabilis y Enterobacter aerogenes (Deka et al. 2018). Por otro lado, nuevos biomateriales basados en quitosano entrecruzado con polivinilpirrolidona dendronizado con weisocianato y cargado con ciprofloxacina, como fármaco modelo, se usaron para preparar películas bioadhesivas. Se evaluaron in vitro/in vivo las propiedades más relevantes para definir las principales características fisicoquímicas y biofarmacéuticas para aplicaciones tópicas de curación de heridas. Se observó una liberación prolongada de CIP y comportamientos diferentes de los perfiles de liberación, dependiendo de la presencia del dendrón. Las películas cargadas con CIP fueron efectivas para inhibir el crecimiento de bacterias Gram+ y Gram- . Además, la biocompatibilidad y la bioadhesión dentro de los sacos conjuntivales de los conejos sugieren que estas películas tienen buenas propiedades para aplicaciones tópicas sobre las heridas de la piel, permitiendo menor frecuencia de administración y mejorando el tiempo de residencia de las películas (García et al. 2017).
237 Desarrollo D e Biomateriales
3.5 Almidón
El uso del almidón como materia prima para la preparación de películas ha sido intensamente estudiado en las últimas décadas, especialmente por el potencial del uso como polímero natural económico y renovable. Como ejemplo, para desarrollar películas de almidón, se usaron desechos del procesamiento del jugo de arándanos mediante moldeo por compresión (Leites Luchese et al. 2018a). El proceso de compresión permitió la formación de películas hidrófobas con ángulos de contacto incluso superiores a 100°, para las películas preparadas con el mayor contenido de residuos de arándanos. La solubilidad de las películas se redujo por la incorporación de residuos de arándanos, independientemente del pH de la solución. Estas películas mostraron buenas propiedades de barrera contra la luz UV debido a los compuestos aromáticos presentes en los residuos de arándanos. En otro trabajo, se incorporaron diferentes cantidades de orujo de arándano (BP) en las soluciones formadoras de película de almidón de yuca (CS) y se investigaron las propiedades térmicas, ópticas y físico químicas de las películas preparadas mediante casting (Leites Luchese et al. 2018b).
Las películas con BP incorporado, mostraron buenas propiedades de barrera contra la luz, mostrando su efecto beneficioso para prevenir el deterioro de los alimentos causado por la radiación UV cuando las películas son usadas para aplicaciones de envasado de alimentos. Estos resultados se relacionaron con la presencia de compuestos aromáticos en BP, pudiendo absorber la luz en longitudes de onda por debajo de 300 nm. Además, todas las películas mantuvieron su integridad estructural después de la inmersión en agua (24 h) y el máximo hinchamiento fue inferior al 300%. Además, la liberación de compuestos activos de BP en simulantes de alimentos (después de 10 días) mostró mayor migración en el medio de ácido acético en comparación con el etanólico. La incorporación de BP a la solución formadora de película de CS resultó en el mejoramiento de las mismas, lo que sugiere la posible aplicación de estas películas como envases activos.
4. UTILIZACIÓN COMO MATERIALES DE REFUERZO
Como se ha visto anteriormente, los componentes extraídos de residuos o subproductos de bajo valor de industrias agroalimentarias pueden ser utilizado como material base para la preparación de biomateriales con potenciales aplicaciones como recubrimientos de características biodegradables o incluso comestibles o para su utilización en ingeniería de tejidos o dispositivos de liberación controlada de fármacos. Sin embargo, muchos otros componentes pueden ser aislados u obtenidos a partir de estos derivados agroindustriales. Este es el caso de materiales nanométricos en forma de cristales o fibras que pueden ser aislados de residuos que contengan una gran proporción de celulosa o almidón y que pueden
238 Desarrollo sostenible
ser utilizados para reforzar biomateriales o incluso materiales sintéticos para cumplimentar con el objetivo de optimizar sus propiedades generales (Kargarzadeh et al. 2017).
4.1 Utilización de residuos agroalimentarios ricos en celulosa y almidón
Se encuentra extensamente descripta en literatura la utilización de residuos agroindustriales que se producen en gran volumen (biomasa) y que actualmente cumplen funciones como alimento de engorde animal o simplemente de uso fertilizante en suelos. Por ejemplo, este es el caso de los subproductos que se producen en mayor volumen en el cultivo e industrialización de la soja. En Argentina se produce gran cantidad de biomasa formada por subproductos como la cascarilla del grano o las vainas que quedan sobre los campos sin recolectar que poseen un elevado contenido de derivados de celulosa. A partir de estos, es posible la obtención de nanocristales o nanofibras cuyas propiedades de refuerzo de biomateriales se encuentran en estudio en la actualidad.
Estos nanomateriales pueden ser obtenidos a partir de tratamientos mecánicos o enzimáticos pero el tratamiento químico es el más utilizado en la actualidad. El mismo se basa en la hidrólisis ácida de los sectores amorfos logrando materiales enriquecidos en zonas cristalinas. A partir de esto se obtienen dispersiones blancas y estables en el tiempo de nanofibras de celulosa de aproximadamente 20 nm de ancho y 500 nm de largo, con un marcado aumento en el índice de cristalinidad en comparación con la materia prima (González et al. 2019). Estas nanofibras han sido utilizadas para reforzar películas de proteínas de soja (Fig. 5). Estos autores prepararon soluciones filmogénicas de SPI utilizando glicerol como plastificante y diferentes cantidades de nanofibras de celulosa.




Figura 5. Aspecto de películas de proteinas de soja conteniendo nanorrefuerzos en diferentes cantidades: (0, 10, 20 y 40% para A, B, C y D, respectivamente).
El comportamiento reológico de las soluciones filmogénicas que contienen nanofibras sugirió una interacción importante entre la matriz y los refuerzos. Se obtuvieron películas por casting con una superficie homogénea,
239 Desarrollo D e Biomateriales
A
D
B C
observándose por un gran número de nanofibras presentes y mostrando una opacidad creciente en muestras con cantidades mayores de nanofibras de celulosa. Las propiedades mecánicas mejoraron notoriamente, así como también disminuyó la susceptibilidad de las películas por el agua. Se logró determinar un aumento en el ángulo de contacto, lo que demuestra un aumento de la hidrofobicidad de las mismas con el agregado de las nanofibras.
La explicación de este efecto viene dada debido a la compatibilidad existente en la interface matriz proteica/nano refuerzo. El carácter polar similar de ambos componentes conduce probablemente a una fuerte adhesión entre la proteína y la celulosa (enlaces puente hidrógeno, entre otras) minimizando las interacciones de la matriz con el solvente acuoso. Este efecto es más marcado mientras mayor es la cantidad de nano refuerzo presente. Por otro lado, la gran magnitud de los cambios observados radica en el hecho de que la interface existente es extremadamente extensa, producto del pequeño tamaño del refuerzo agregado, por lo que las interacciones toman mayor protagonismo (Dufresne 2010).
Una gran producción de biomasa en forma de residuo o subproducto derivado de la industria agroalimenticia, destinada en la actualidad sólo a alimentación animal es la producida a partir del pelado de granos, semillas, legumbres y oleoginosas derivada de la comercialización de granos pelados. Como ya se mencionó la utilización de cascarillas de soja (Fig. 6A), otras cadenas agroalimentarias también producen este residuo en gran volumen. Entre ellas también se encuentra el caso del arroz. Se pueden encontrar reportes en literatura que describen la obtención de nanofibras y nanocristales de celulosa a partir de los restos de la planta de arroz (Fig. 6B) que queda en los campos al momento de la cosecha. En este caso, las nanofibras de celulosa fueron preparadas a partir del tratamiento químico de la paja de arroz tratada previamente con vapor. Las nano y microfibras (CMF y CNF) obtenidas fueron a su vez oxidadas y se utilizaron para preparar el biocomposito de alcohol polivinílico (PVA). Los autores observaron que las CNF de paja de arroz se dispersan de manera homogénea, mientras que los CMF exhiben grandes agregados, lo que hace que las películas compuestas de CNF / PVA muestren menor opacidad y una mayor mejora de la resistencia mecánica que las películas compuestas de CMF / PVA (Wang et al., 2018). Johar et al. (2012) determinaron la composición química de la cáscara de arroz y encontrando que su contenido de celulosa era del 31%. La purificación de la celulosa la realizaron mediante tratamientos químicos clásicos que involucran tratamientos alcalinos y de blanqueo. Ellos observaron que el primer tratamiento fue eficaz para eliminar la hemicelulosa, mientras que el último eliminó completamente la lignina. Los autores extrajeron con éxito nanocristales de celulosa de la cáscara de arroz purificada utilizando un tratamiento de hidrólisis ácida. Su diámetro osciló entre 10 y 15 nm. Un solo reporte habla sobre la obtención de CNF a partir de cascarillas de café donde los contenidos de celulosa de las cáscaras de café fueron de 34-
240 Desarrollo sostenible
35%, lo que las convierte en una buena fuente de material celulósico para diferentes usos industriales. Las fibras de café fueron más planas y más dobladas helicoidalmente que las fibras de arroz. La hidrólisis ácida de las fibras dio lugar a nanocristales (CNC). Los CNC de cáscara de café fueron de 20 nm de diámetro promedio con una relación de aspecto superior a 10. Los CNC resultaron muy adecuadas como materiales de refuerzo en materiales compuestos de biopolímeros, mostrando aumentos del módulo elástico en películas de almidón termoplástico en un 121% (Collazo-Bigliardi et al. 2018).
Otra fuente de residuos provenientes de la industria agroalimenticia es la derivada de los procedimientos de pelado de frutas y verduras. La industrialización de las mismas para la producción de dulces, conservas y otros derivados produce grandes volúmenes de biomasa en forma de piel o cáscaras de frutas. A partir de estos residuos también pueden extraerse componentes celulósicos para la preparación de biopelículas o nanorrefuerzos. Tal es el caso de la utilización de la piel de banana, pomelo, granada y tuna para el desarrollo de biopelículas destinadas al recubrimiento de alimentos o tomate, papa, mandarina, mango y ananá para la extracción de nanorefuerzos de celulosa (Chen et al. 2012, Jiang y Hsieh 2015, Wijaya et al. 2017).
Faria Arquelau et al. (2019) reportaron la extracción de harinas ricas en almidón de la piel de bananas para la preparación de biopelículas, variando la concentración de almidón de maíz (33,3–66,6% p/p). Los autores estudiaron la variación en el contenido de almidón y temperatura de calentamiento en el espesor, color, opacidad, solubilidad, y propiedades de barrera y mecánicas mostrando variaciones importantes y buenas propiedades generales. La producción de bagazo provenientes de diversas fuentes vegetales también forma parte de la gran variedad de subproductos o residuos derivados de las industrias agroalimentarias.
El bagazo de caña de azúcar, se pueden obtener en grandes cantidades en las industrias de azúcar y alcohol. Normalmente, el bagazo de caña de azúcar se utilizada como combustible para generar energía para la molienda. Sin embargo, una gran cantidad del bagazo restante no se utiliza y se quema en los campos lo cual puede causar problemas ambientales. El bagazo de caña de azúcar contiene aproximadamente un 33,5% de hemicelulosas, por lo que diversas investigaciones han sido orientadas hacia la búsqueda de biopelículas preparadas a partir de este polisacárido el cual es extraído mediante tratamientos alcalinos. Sabiha-Hanim y Siti-Norsafurah (2012) reportaron la obtención de películas las cuales mostraron buena potencialidad para ser usadas como recubrimiento de alimentos principalmente por sus buenas propiedades mecánicas y de barrera.
El bagazo de caña de azúcar ha sido también investigado con el objetivo de preparar nanocelulosa para aplicaciones en biomateriales. Por ejemplo, nanocristales de celulosa extraídos de bagazo de caña de azúcar fueron incorporados a películas de proteína de suero (residuo de la industria láctea)
241 Desarrollo D e Biomateriales
para desarrollar materiales de empaque. Respecto a los residuos generados por el cultivo de sorgo, Stoklosa et al. (2019) reportaron la obtención de arabinoxilanos a partir del salvado, bagazo y biomasa de sorgo los cuales fueron estudiados por su capacidad de formación de biopelículas, mostrando distintas propiedades de acuerdo a las distintas fracciones de arabinoxilanos extraídas. Otro biocompuesto capaz de formar nanorefuerzos y optimizar las propiedades generales de biopelículas de origen natural es el almidón. Muchas investigaciones se relacionan a la obtención de nanocristales de almidón a partir de papa, maíz, trigo, mandioca o arvejas para el refuerzo de películas naturales o sintéticas (Lin et al. 2011). Por ejemplo, nanocristales fueron preparados mediante la hidrólisis ácida de almidón de papa con el fin de reforzar películas de proteínas de soja. Estas películas resultaron homogéneas donde la opacidad y el grado de cristalinidad aumentaron con la cantidad de nanocristales. Se reportó un efecto marcado producido por el agregado de nanocristales el cual producía una menor afinidad por el agua en las películas. Además, se determinaron las propiedades mecánicas las cuales mostraron que las películas reforzadas fueron más resistentes (González y Alvarez Igarzabal 2015).


Figura 6. Imágenes tomadas con un microscopio de transmisión electrónica de nanofibras obtenidas a partir de cascarillas de soja (A) y salvado de arroz (B).
4.2 Compuestos activos para el desarrollo de envases activos e inteligentes
Los envases alimentarios han ido cambiando a lo largo del tiempo, como respuesta a los cambios en la forma de vida. Contrariamente al concepto de envase pasivo tradicional, el envase activo es el que interacciona directamente con el alimento y/o con su entorno para mejorar aspectos de su calidad o seguridad. Incorporando agentes activos como antimicrobianos o antioxidantes se modifican las condiciones de conservación de los productos, para mantener su calidad, mejorar atributos sensoriales, y aumentar su duración y conservación (González 2013). Por otro lado, los envases inteligentes tienen la particularidad de controlar e informar al consumidor las anormalidades o su-
242
Desarrollo sostenible
A B
cesos inadecuados que han ocurrido durante el procesado, transporte, distribución o almacenamiento del alimento actuando como alerta del posible mal estado o degradación de su calidad, reaccionando a las condiciones de entorno a las que son sometidos los envases (Schaefer y Cheung 2018). En una extensa revisión, Ribeiro-Santos et al. (2017) proporcionan una visión concisa y crítica sobre el uso de aceites esenciales (AE) en aplicaciones alimentarias, principalmente en envases activos. Dichos AE, son compuestos naturales complejos, volátiles, generalmente lipofílicos que han sido objeto de numerosas investigaciones debido a su potencial en la industria de alimentos, por presentar una correcta eficacia en pruebas antimicrobianas y antioxidantes y por poder ser extraídos de residuos de la industria agroalimentaria (materia prima de bajo valor) (Yu et al. 2018). En general, estos compuestos prolongan la estabilidad útil de los alimentos durante el almacenamiento, inhibiendo el crecimiento de microorganismos patógenos y lo protegen contra la oxidación. Entre los más frecuentemente utilizados se encuentra el timol, del tomillo (Thymus vulgaris) (Marchese et al. 2016), el carvacrol del orégano (Origanum vulgare) (Salehi et al. 2019), alina y alicinas del ajo (Allium sativum) (Sharma et al. 2019), mentol extraído de la menta (Mentha piperita) (Ju et al. 2019) y cinamaldehido de la canela (Cinnamomun zeylanicum) (Shreaz et al. 2016). Por otra parte, los resultados obtenidos a partir de la preparación de biopelículas a partir de harinas extraídas de cáscara de pomelo indican que este residuo agroalimentario puede usarse como un buen sustrato formador de película, mostrando buenos valores respecto a sus propiedades mecánicas y de barrera al agua. Los autores ensayaron además la utilización de extractos de té para incorporarle a las películas propiedades antioxidantes y antimicrobianas determinadas mediante ensayos in-vitro. En general, las películas compuestas con un 10% de polifenoles de té mostraron propiedades de combinación excelentes debido a interacciones intermoleculares fuertes y a una microestructura compacta, mostrando una aplicación potencial como materiales de envasado bioactivos amigables con el medio ambiente (Wu et al. 2019. Películas antimicrobianas pueden ser obtenidas mediante el agregado de piel de granada las cuales muestran buenos resultados en la inhibición del crecimiento de films S. aureus y Salmonela (Ali et al. 2019). Películas biodegradables e inteligentes fueron desarrolladas a partir de almidón de yuca, glicerol y residuos de arándanos (obtenidos del procesamiento del jugo). La diferencia de color del indicador, que resultó perceptible para el ojo humano, se evaluó en diferentes soluciones de variados valores de pH, simulantes y alimentos. Los resultados mostraron el uso potencial de los films desarrollados conteniendo residuos agroindustriales como indicador de pH (Leites Luchese et al. 2018c). Otras películas indicadoras de pH colorimétrico fueron desarrolladas por Choi et al. (2017) a partir de agar, almidón de patata y colorantes naturales (antocianinas) extraídos de batata púrpura. Las variaciones de color de las películas indicadoras de pH se midieron en solucio-
243 Desarrollo D e Biomateriales
nes de diferentes valores de pH y se realizaron ensayos de aplicación para uso como sensor de deterioro de la carne. Las películas mostraron cambios en el pH y punto de deterioro de las muestras de cerdo, cambiando de rojo a verde, concluyendo que las mismas podrían utilizarse como herramienta de diagnóstico para la detección de deterioro de los alimentos. Otros biomateriales de características minerales pueden ser obtenidos a partir de un residuo muy abundante de la industria alimenticia como lo son las cáscaras de huevo. La hidroxiapatita puede ser sintetizada a partir de este residuo mediante un método hidrotérmico. El producto obtenido es una mezcla de hidroxiapatita y CaHPO4 en una proporción de 3:1. Los autores aseguran que las características fisicoquímicas de las hidroxiapatitas obtenidas las hacen adecuadas para su uso en prótesis dentales (Elizondo-Villarreal et al. 2012).
CONSIDErACIONES FINALES
Como puede ser observado en este capítulo, la revalorización de los residuos o subproductos generados por industria agroalimentaria se encuentra bajo estudio en el ámbito académico y empieza a ser implementado a nivel industrial en busca de desarrollos más sustentables, amigable con el medio ambiente y económicamente favorables, acordes a las exigencias que nos tocan vivir en los tiempos actuales.
r EFERENCIAS BIBLIOGR Á FICAS
ASTM Standard D5988 (2012) Standard test method for determining aerobic biodegradation of plastic materials in soil. ASTM International. West Conshohocken. doi:10.1520/D5988-12. www.astm.org.
Ali A et al. (2019) Starch-based antimicrobial films functionalized by pomegranate peel. International Journal Biological Macromolecules, 129:1120-1126.
Bourtoom T (2008) Edible films and coatings: characteristics and properties. International. Food Research Journal, 15(3):237-248.
Carpiné D, Dagostin JL, Bertan L, Mafra M (2015) Development and Characterization of Soy Protein Isolate Emulsion-Based Edible Films with Added Coconut Oil for Olive Oil Packaging: Barrier, Mechanical, and Thermal Properties. Food and Bioprocess Technology, 8:1811-1823.
Chen D, Lawton D, Thompson MR, Liu Q (2012) Biocomposites reinforced with cellulose nanocrystals derived from potato peel waste. Carbohydrate Polymers, 90(1):709–716.
Choi SG et al. (2003) Molecular dynamics of soy-protein isolate films plasticized by water and glycerol. Journal of Food Science, 68:2516–2522.
Choi I et al. (2017) Intelligent pH indicator film composed of agar/potato starch and anthocyanin extracts from purple sweet potato. Food Chemistry, 218:122–128.
244
Desarrollo sostenible
Collazo-Bigliardi S et al. (2018) Isolation and characterisation of microcrystalline cellulose and cellulose nanocrystals from coffee husk and comparative study with rice husk. Carbohydrate Polymers, 191:205-215.
Dhanasekaran S, Rameshthangam P, Venkatesan S (2018) In Vitro and In Silico Studies of Chitin and Chitosan Based Nanocarriers for Curcumin and Insulin Delivery. Journal of Polymers and the Environment, 26:4095-4113.
Deka C, Deka D, Bora MM, Jha D, Kakati D (2018) Investigation of pH-Sensitive Swelling and Curcumin Release Behavior of Chit-glc Hydrogel. Journal of Polymers and the Environment, 26:4034-4045.
Denavi G et al. (2009) Effects of drying conditions on some physical properties of soy protein films. Journal of Food Engineering, 90:341–349.
Dufresne A et al. (2010) Processing of Polymer Nanocomposites Reinforced with Polysaccharide Nanocrystals. Molecules, 15:4111–4128.
Elizondo-Villarreal (2012) Biomaterials from Agricultural Waste: Eggshell-based Hydroxyapatite. Water, Air, & Soil Pollution, 223:3643–3646
El Knidri et al. (2018) Extraction, chemical modification and characterization of chitin and chitosan. International Journal of Biological Macromolecules, 120:1181-8130.
Etxabide A, Uranga J, Guerrero P, de la Caba K (2017) Development of active gelatin films by means of valorisation of food processing waste: A review. Food Hydrocolloids, 68:192-198.
Faria Arquelau PB et al. (2019) Characterization of edible coatings based on ripe “Prata” banana peel flour. Food Hydrocolloids, 89:570-578.
García M et al. (2017) Bioadhesive and biocompatible films as wound dressing materialsbased on a novel dendronized chitosan loaded with ciprofloxacin. Carbohydrate Polymers, 175:75–86.
García Schejtman et al. (2015) Gelatin films dendronized selectively on one side: enhancing antimicrobial properties and water repellence. Polymer Bulletin, 72(12):3043-3062.
Gennadios A et al. (1993) Temperature effect on oxygen permeability of edible protein-based films. Journal of Food Science, 58(1):212-214.
Geyer R, Jambeck JR, Lavender Law K (2017) Production, use, and fate of all plastics ever made. Science Advances, 3(7):e700782.
Gomes dos Santos FK et al. (2017) Effect of the Addition of Carnauba Wax on Physicochemical Properties of Chitosan Films. Materials Research, 20:479484.
González A (2013) Materiales poliméricos biodegradables para ser usados en recubrimientos: preparación por modificación de materiales de origen natural. Tesis Doctoral. Universidad Nacional de Córdoba. Córdoba, Argentina.
González A, Alvarez Igarzabal CI (2013) Soy protein - poly (lactic acid) bilayer films as biodegradable material for active food packaging. Food Hydrocolloids, 33:289-296.
González A, Alvarez Igarzabal CI (2015) Nanocrystal-reinforced soy protein films and their application as active packaging. Food Hydrocolloids 43:777–784.
González A, Alvarez Igarzabal CI (2017) Study of graft copolimerization of soy protein-methyl methacrylate. Preparation and characterization of grafted films. Journal of Polymers and the Environment, 25 (2):214–220.
245 Desarrollo D e Biomateriales
González A, Strumia MC, Alvarez Igarzabal CI (2011) Cross-linked Soy Protein as Material for Biodegradable Films: Synthesis Characterization and Biodegradation. Journal Of Food Engineering, 106: 331–338.
González A, Tártara LI, Palma SD, Alvarez Igarzabal CI (2015) Crosslinked soy protein films and their application as ophthalmic drug delivery system. Materials Science and Engineering: C, 51:73-79.
González A et al. (2019) Preparation and characterization of soy protein films reinforced with cellulose nanofibers obtained from soybean by-products. Food Hydrocolloids, 89:758-764.
Isaschar-Ovdat S, Fishman A (2018) Crosslinking of food proteins mediated by oxidative enzymes – A review. Trends in Food Science & Technology, 72:134143.
Jiang F, Hsieh Y (2015) Cellulose nanocrystal isolation from tomato peels and assembled nanofibers. Advanced Materials Interfaces, 122:60-68.
Johar N, Ahmad I, Dufresne A (2012) Extraction, preparation and characterization of cellulose fibres and nanocrystals from rice husk. Industrial Crops and Products, 37(1):93-99.
Ju J et al. (2019) Application of essential oil as a sustained release preparation in food packaging. Trends in Food Science & Technology, 92:22-32.
Kargarzadeh H et al. (2017) Recent developments on nanocellulose reinforced polymer nanocomposites: A review. Polymers, 132:368–393.
Koshy RR, Mary SK, Thomas S, Pothan LA (2015) Environment friendly green composites based on soy protein isolate – A review. Food Hydrocolloids, 50:174-192.
Leites Luchese C et al. (2018a) Valorisation of blueberry waste and use of compression to manufacture sustainable starch films with enhanced properties International. Journal of Biological Macromolecules, 115:955–960.
Leites Luchese CL et al. (2018b) Development and characterization of cassava starch films incorporated with blueberry pomace. International Journal of Biological Macromolecules, 106:834-839.
Leites Luchese C, Ferreira Abdalla V, Corralo Spada J, Tessaro IC (2018c) Evaluation of blueberry residue incorporated cassava starch film as pH indicator in different simulants and foodstuffs. Food Hydrocolloids, 82:209-218.
Lin N, Huang J, Chang PR, Anderson DP, Yu J (2011) Preparation, modification, and application of starch nanocrystals in nanomaterials: a review. Journal of Nanomaterials, 13p.
Marchese A et al. (2016) Antibacterial and antifungal activities of thymol: A brief review of the literature. Food Chemistry, 210:402-414.
Marquié C (2001) Chemical reactions in cottonseed protein cross-linking by formaldehyde, glutaraldehyde and glyoxal for the formation of protein films with enhanced mechanical properties. Journal of Agricultural and Food Chemistry, 49(10):4676-4681.
Martucci JF, Ruseckaite RA, Vázquez A (2006) Creep of glutaraldehyde-crosslinked gelatin film. Materials Science and Engineering, 435:681–686.
Park SK, Bae D H, Rhee KC (2000) Soy protein biopolymers cross-linked with glutaraldehyde. Journal of the American Oil Chemists Society, 77(8):879–884.
246 Desarrollo sostenible
Picchio ML et al. (2018a) Crosslinked casein-based micelles as a dually responsive drug delivery system. Polymer Chemistry, 9:3499-3510.
Picchio ML et al. (2018b) pH-responsive casein-based films and their application as functional coatings in solid dosage formulations. Colloids and Surfaces A, 541:1-9.
Picchio ML et al. (2018c) Casein films crosslinked by tannic acid for food packaging applications. Food Hydrocolloids, 84:424-434.
Puppo MC, Gularte MA, Pérez G, Ribotta PD, Añón MC (2007) Soja en detallesGranos, Harinas Y Productos de Panificación en Hiberoamérica, pp.321–361.
Ribeiro-Santos R et al. (2017) Use of essential oils in active food packaging: Recent advances and future trends. Trends in Food Science & Technology, 61:132-140.
Rodríguez AG. Mondaini AO, Hitschfeld MA (2017) Bioeconomía en América Latina y el Caribe: contexto global y regional y perspectivas. En: Boletín de la Comisión Económica para América Latina y el Caribe (CEPAL), CEPAL, Santiago de Chile. pp.96.
Sabbah M et al. (2019) Chapter 21 - Transglutaminase Cross-Linked Edible Films and Coatings for Food Applications. In: Enzymes in Food Biotechnology. Production, Applications, and Future Prospects. Academic Press, Londres. pp.369-388.
Sabiha-Hanim S, Siti-Norsafurah AM (2012) Physical Properties of Hemicellulose Films from Sugarcane Bagasse. Procedia Engineering, 42:1390-1395.
Saheb M et al. (2019) Chitosan-based delivery systems for curcumin: A review of pharmacodynamic and pharmacokinetic aspects. Journal of Cellular Physiology, 234(8): 12325-12340.
Salehi B et al. (2019) Thymus spp. plants - Food applications and phytopharmacy properties. Trends in Food Science & Technology, 85:287-306.
Schaefer D, Cheung WM (2018) Smart Packaging: Opportunities and Challenges. Procedia CIRP, 72: 1022-1027. doi.org/10.1016/j.procir.2018.03.240.
Sharma S, Cheng S, Bhattacharya B, Chakkaravarthi S (2019) Efficacy of free and encapsulated natural antioxidants in oxidative stability of edible oil: Special emphasis on nanoemulsion-based encapsulation. Trends in Food Science and Technology, 91:305-318.
Shreaz S, Wani WA, Behbehani JM, Raja V, Hun LT (2016) Cinnamaldehyde and its derivatives, a novel class of antifungal agents. Fitoterapia, 112:116-131.
Song F, Zhang LM (2009) Gelation modification of soy protein isolate by a natural occurring cross-linking agent and its potential biomedical application. Advanced Materials Interfaces, 48(15):7077–7083.
Stoklosa RJ, Latona RJ, Bonnaillie LM, Yadav M (2019) Evaluation of arabinoxylan isolated from sorghum bran, biomass, and bagasse for film formation. Carbohydrate Polymers, 213: 382-392.
Tang CH (2019) Nanostructured soy proteins: Fabrication and applications as delivery systems for bioactives (a review). Food Hydrocolloids, 91:92-116.
Tian H, Guo G, Fu X, Yao Y, Yuan L, Xiang A (2018) Fabrication, properties and applications of soy-protein-based materials: A review. International Journal of Biological Macromolecules, 120:475-490.
247 Desarrollo D e Biomateriales
Tongdeesoontorn W, Rawdkuen S (2019) Gelatin-Based Films and Coatings for Food Packaging Applications. Coatings, 6(4), 41-55.
Vaz MC (2005) Processing and characterization of biodegradable soy plastics: effect of cross-linking with glyoxal and thermal treatment. Journal of Applied Polymer Science, 97(2):604-610.
Wang, Z, Qiao X, Sun K (2018) Rice straw cellulose nanofibrils reinforced poly(vinyl alcohol) composite films. Carbohydrate Polymers, 197:442-450.
Wei M., Gao Y, Li X, Serpe MJ (2017) Stimuli-responsive polymers and their applications. Polymer Chemistry, 8:127-143.
Wijaya CJ et al. (2017) Cellulose nanocrystals from passion fruit peels waste as antibiotic drug carrier. Carbohydrate Polymers, 175:370-376.
Wu H et al. (2019) Preparation and characterization of bioactive edible packaging films based on pomelo peel flours incorporating tea polyphenol. Food Hydrocolloids, 90:41-49.
Yu Z, Sun L, Wang W, Zeng W, Mustapha A, Lin M (2018) Soy protein-based films incorporated with cellulose nanocrystals and pine needle extract for active packaging. Industrial Crops & Products, 112:412–419.
248 Desarrollo sostenible
TÉCNICAS
AMIGABLES CON EL MEDIO AMBIENTE
PARA LA DESCONTAMINACIÓN DE FRUTAS FINAS
Franco Van de Velde1, 2 , María P. Méndez-Galarraga1, 2, Andrea M. Piagentini1 , María E. Pirovani1
1 Universidad Nacional del Litoral (UNL), Instituto de Tecnología de Alimentos, Facultad de Ingeniería Química, Santiago del Estero 2829, (3000) Santa Fe, Argentina. E-mail: mpirovan@fiq. unl.edu.ar
2 Consejo de Investigaciones Científicas y Técnicas (CONICET), Godoy Cruz 2290, (C1425FQB) CABA, Argentina. E-mail: info@conicet.gov.ar
INTRODUCCIÓN
Las frutas finas o berries como frutillas (Fragaria spp.) y zarzamoras (Rubus spp.), de atractivo color y sabor, aportan a la dieta numerosos compuestos antioxidantes con comprobados beneficios para la salud del consumidor (Jung et al. 2015). Como consecuencia, se ha registrado en Argentina un aumento en la superficie cultivada, en la producción y en el posicionamiento en el mercado de estas frutas. Se trata de producciones intensivas en mano de obra y capital, que generan alta rentabilidad en pequeñas superficies y son movilizadoras de las economías locales y regionales (Gómez Riera et al. 2013). Como contrapartida, las frutillas y las zarzamoras poseen una vida postcosecha extremadamente corta, ya que son susceptibles al daño mecánico, deterioro fisiológico y microbiológico y a la pérdida de agua (Ramos et al. 2013). Principalmente, los microorganismos alterantes, presentes en la microbiota nativa, pueden causar hasta el 15% de las pérdidas postcosecha de frutas y hortalizas. Las principales alteraciones postcosecha de frutillas y zarzamoras, de menor pH que las hortalizas, se deben principalmente a mohos, siendo los géneros más frecuentes Alternaria, Aspergillus, Botrytis, Fusarium Penicillium, y Rhizopus (Ramos et al. 2013, Vardar et al. 2012).
Además de los microorganismos que producen pérdida de calidad, pueden estar también presentes microorganismos patógenos para el hombre, afectando la seguridad de estos productos. Los expertos en nutrición aconsejan aumentar el consumo de frutas y hortalizas frescas o mínimamente procesadas por sus comprobados beneficios para la salud (Lynch et al. 2009). Por estos motivos, los consumidores perciben a estos alimentos como seguros y saludables, pero a menudo no son conscientes de los riesgos derivados de la presencia de microorganismos patógenos en los mismos. Los microorganismos
249 15
Stadnik
la Producción
MJ, Velho AC, Zorrilla SE (eds.) Desarrollo Sostenible en
Agroalimentaria
más frecuentemente vinculados a brotes relacionados con el consumo de frutas y hortalizas incluyen bacterias (Salmonella spp., Listeria monocytogenes, Escherichia coli y Shigella spp.), virus y parásitos (Ramos et al. 2013). La asociación de estos microorganismos con brotes relacionados a frutas y hortalizas frescas o mínimamente procesadas, demuestra la falta de un protocolo eficaz de lavado y/o desinfección.
1. T ÉCNICAS DE DESCONTAMINACIÓN DE FRUTAS y HORTALIZAS
El mejor método para reducir la población de microorganismos en frutas y hortalizas es, sin dudas, prevenir la contaminación. Sin embargo, esto no siempre es posible y el uso de técnicas de descontaminación constituye una de las etapas de procesamiento más críticas sobre todo en el mínimo procesamiento, ya que afecta la calidad, la seguridad y la vida útil del producto.
Varios compuestos químicos están disponibles comercialmente para su uso en la etapa de lavado y/o desinfección, siendo el cloro y sus derivados las alternativas más comunes y económicas. Los compuestos clorados se usan ampliamente en la industria de frutas y hortalizas enteras y mínimamente procesadas con el objetivo de controlar el número de microorganismos en el agua de lavado y reducir la contaminación superficial mejorando la calidad microbiológica de estos productos (Pirovani et al. 2006).
El espectro de microorganismos eliminados o inhibidos por los compuestos a base de cloro es probablemente más amplio que el de cualquier otro desinfectante aprobado. En solución, la eficiencia del cloro puede verse afectada por el pH y la materia orgánica, pero también por las propiedades de la superficie del producto. Además, su subutilización no proporciona ningún efecto en la población microbiana, mientras que su uso excesivo puede interferir con las propiedades fisiológicas, sensoriales, nutricionales y fitoquímicas, o generar subproductos tóxicos. Es decir, el uso inadecuado del cloro puede afectar la calidad y la vida útil de los productos frescos y mínimamente procesados (Chaidez et al. 2012). Por esta razón, se busca reemplazarlo por desinfectantes alternativos ya que la reacción del cloro con la materia orgánica podría resultar en la formación de trihalometanos y otros compuestos potencialmente carcinógenos (Silveira et al. 2008). Es así que el ácido peracético (APA) ha ganado interés como agente desinfectante de frutas y hortalizas frescas enteras o mínimamente procesadas (Vandekinderen et al. 2008, Van de Velde et al. 2010). Comercialmente, el APA está disponible como una mezcla líquida cuaternaria en equilibrio de ácido acético, peróxido de hidrógeno, ácido peracético y agua. El APA es un líquido transparente e incoloro, sin capacidad de formación de espuma y cuyos productos de descomposición reportados son ácido acético y oxígeno, por lo que se lo considera respetuoso con el medio ambiente (Silveira et al. 2008, Vandekinderen et al. 2009). Las ventajas del uso de este desinfectante sobre otros agentes, como el cloro, incluyen la falta o
250 desarrollo
sostenible
sólo una formación insignificante de compuestos tóxicos o carcinogénicos, que su actividad está poco influenciada por la presencia de material orgánico y que no depende de factores tales como el pH y la temperatura (Lee y Huang 2019, Vandekinderen et al. 2009). Las soluciones de APA pueden ser agentes fuertemente oxidantes. Los potenciales de óxido-reducción del APA y del peróxido de hidrógeno (H2O2) son de alrededor de 1,8 eV, siendo estos potenciales mayores que los del ácido hipocloroso (1,49 eV) o el dióxido de cloro (0,49 eV) (Pechacek et al. 2015). Las soluciones de APA se utilizan para el lavado de frutas y hortalizas en concentraciones autorizadas de hasta 80 mg/L (CFR 2018). La eficiencia del APA sobre los microorganismos, en orden decreciente es: bacterias> virus> esporas bacterianas> quistes de protozoos (Kitis 2004).
En resumen, el APA presenta ventajas importantes para su elección ya que es un germicida efectivo, es soluble en agua, requiere bajas concentraciones de uso con un costo moderado (aunque mayor que el del hipoclorito de sodio), no afecta el medio ambiente, no deja residuos tóxicos, es activo en presencia de materia orgánica y aguas duras y el almacenamiento de la solución concentrada es estable durante largo tiempo (Baldry 1983, Kunigk y Almeida 2001). Además, puede usarse en un amplio espectro de pH (3,0 – 7,5) y el proceso de desinfección puede llevarse a cabo a temperatura ambiente, siendo activo aun a temperaturas tan bajas como 0 °C (Kunigk y Almeida 2001).
La selección de una técnica adecuada de lavado para reducir la carga microbiológica de frutas y hortalizas depende de muchos factores tales como la carga microbiana inicial en la superficie de los productos, la superficie a tratar, el tipo de desinfectante, ubicación de microorganismos contaminantes, concentración, tiempo y temperatura de exposición al desinfectante (Beuchat et al. 2004). Además se debe considerar que cuando una operación de lavado no está diseñada y/o realizada adecuadamente, puede crear lesiones en la superficie del tejido vegetal, producir contaminación cruzada y/o internalización de contaminantes microbiológicos y químicos, así como generar pérdidas de pigmentos, vitaminas y compuestos importantes para la salud por oxidación y/o lixiviación.
Existen diferentes técnicas para producir el contacto entre la fruta y el agente desinfectante: por inmersión, por aspersión y por nebulización. En cada una de estas técnicas se pueden determinar las combinaciones de las variables operativas que permitan lograr la desinfección deseada sin pérdida de calidad ni potencial saludable. Es por esto que en este capítulo se presentarán diferentes tecnologías para la aplicación de APA en la etapa de lavado y/o desinfección de frutillas y zarzamoras, analizando principalmente su eficacia para reducir los niveles de contaminación inicial de las frutas frescas enteras y mínimamente procesadas. Además, se abordará el efecto de cada una de las técnicas sobre otros aspectos de la calidad y sobre el potencial saludable de ambas frutas, señalando sus ventajas y limitaciones.
251
D e frutas finas
Descontaminación
2. L AVADO - DESINFECCIÓN POR INMERSIÓN
La técnica de inmersión de las frutas y hortalizas en una solución de lavado es una modalidad muy frecuentemente utilizada en la operación de lavado-desinfección, tanto de productos enteros como mínimamente procesados. Esta etapa tiene como objetivo reducir los microorganismos presentes en la superficie del producto y todo material extraño (tierra, restos de hojas, insectos, etc.). En el caso de los vegetales cortados también se pretende reducir los fluidos celulares que pudieron haberse generado luego del corte (Pirovani et al. 2006). El diseño de los equipos de lavado (agitación, relación de volumen agua/peso de producto, purgas de eliminación para sedimentos, etc.) suele resolver las cuestiones vinculadas a la eliminación de materiales extraños o fluidos celulares. Sin embargo, para cumplir con el objetivo de reducir la carga microbiana, es necesario utilizar agentes sanitizantes. Además, este sanitizante permite mantener bajo el nivel de concentración de microorganismos (carga microbiana) en el agua de lavado que se pone en contacto con la fruta. Como ya se mencionó, el ácido peracético (APA) es una alternativa apropiada si se considera su efectividad en reducir la carga microbiana y su mínima o nula producción de sustancias tóxicas o compuestos cancerígenos durante la operación (Lee y Huang 2019, Silveira et al. 2008, Vandekinderen et al. 2008) . Van de Velde et al. (2014) estudiaron la efectividad del lavado-desinfección con APA de frutillas frescas cortadas var. ‘Camarosa’ sobre la carga microbiológica superficial, analizando el efecto de la concentración (0-100 mg/L), el tiempo de inmersión (0-120 s) y la temperatura de la solución de lavado (440°C), obteniéndose un modelo predictivo. La reducción de microorganismos aerobios mesófilos totales (rAMT) resultó función de la concentración inicial de APA, el tiempo de inmersión y la temperatura de la solución. Los resultados indican que se puede lograr una mayor reducción de microorganismos aerobios mesófilos a medida que se aumenta la concentración de APA y el tiempo de inmersión, con efecto más leve de la temperatura. El modelo predictivo indica que podría alcanzarse 2,6 log de reducción cuando las condiciones de lavado-desinfección son 100 mg/L de APA, 40°C y 120 s (Van de Velde et al. 2014).
Se ha reportado que la efectividad del tratamiento con APA en reducir la carga microbiana depende del tipo de vegetal. Kim et al. (2006) estudiaron la efectividad del lavado con soluciones de 40 y 80 mg/L de APA durante 1 y 5 min para inactivar Enterobacter sakazakii inoculado en la superficie de manzanas, tomates y lechuga. El lavado de manzanas con APA a 40 mg/L durante 1 min a 22°C causó reducciones mayores a 4,00 log. Mientras que el lavado de tomates con APA a la misma concentración (40 mg/L) y misma tempertatura logró reducciones de E. sakazakii mayores a 3,70 log pero durante 5 min. Además, el lavado de lechuga con APA (40 y 80 mg/L) por 5 min a 22°C causó una reducción bacteriana mayor a 5,31 log (Kim et al. 2006).
252 desarrollo sostenible
Van de Velde et al. (2013) demostró que con diferentes variedades de frutillas (‘Camarosa’ y ‘Selva’) la efectividad del tratamiento de desinfección es diferente, utilizándose idénticas condiciones de proceso. Realizando un lavado por inmersión con 100 mg/L de APA, durante 120 s y a 40 °C se logró una rAMT de 2,6 y 1,5 log para las variedades ‘Camarosa’ y ‘Selva’, respectivamente. Estas diferencias en el comportamiento de la reducción de la flora aerobia mesófila frente al sanitizante podrían deberse a varios factores que condicionan la descontaminación de los productos vegetales tales como las condiciones de contaminación, tiempo entre la contaminación y el lavado, unión en sitios inaccesibles, formación de biofilms, internalización de bacterias dentro del producto, entre otros (Sapers 2001).
Otro aspecto que han observado algunos autores es que el impacto del tiempo de inmersión puede variar según sea la concentración de APA. A concentraciones menores de 75 mg/L, Vandekinderen et al. (2009) encontró que el aumento del tiempo (mayor a 4 min) producía un efecto leve sobre la reducción microbiológica. Similarmente, Van de Velde et al. (2013) encontró que a 75 mg/L de APA y 22°C , la reducción de la carga microbiana variaba de 1,4 a 2,1 log cuando el tiempo de inmersión aumentaba de 10 a 65 s, respectivamente. Sin embargo, posteriores extensiones del tiempo de inmersión hasta 120 s sólo permitían alcanzar una reducción a 2,2 log. Más allá de su efecto beneficioso sobre la calidad microbiológica, el lavado-desinfección de las frutas y hortalizas en general y de las frutillas en particular, pueden traer aparejados algunos problemas. Principalmente, podría ocurrir pérdida de pigmentos, vitaminas y otros compuestos (como sólidos solubles) por oxidación y/o lixiviación. Esto puede producir como consecuencia un efecto perjudicial sobre el color al inducir al pardeamiento o la decoloración del tejido vegetal (Vandekinderen et al. 2008). Por lo tanto, la operación de lavado-desinfección puede afectar la calidad general y los nutrientes y compuestos bioactivos del producto. Por todo ello, es esencial que los procesadores sepan cómo impactan las principales variables del proceso y cómo reducir su impacto.
Van de Velde et al. (2013) estudiaron los cambios en los contenidos de antocianinas y compuestos fenólicos totales, ácido ascórbico y vitamina C, para evaluar los compuestos bioactivos y el color, como principal atributo de calidad visual, de frutillas variedades ‘Selva’ y ‘Camarosa’ cortadas en cuartos durante la operación de lavado-desinfección con APA. Las variables estudiadas y sus rangos operativos fueron idénticos a los reportados por Van de Velde et al. (2014). La calidad de ambas variedades de frutillas utilizadas como materia prima, se presentan en la Tabla 1.
253 Descontaminación D e frutas finas
Tabla 1. Compuestos bioactivos, parámetros de calidad y carga inicial de microorganismos aerobios mesófilos totales en frutillas frescas cortadas sin lavar.
Cultivar
Atributo
Media ± desviación estándar. (n=3). AA: ácido ascórbico; Vit C: vitamina C; FT: fenoles totales; AG: ácido gálico; Ant T: antocianinas totales; CA: capacidad antioxidante; SS: sólidos solubles; AT: acidez total; ACA: ácido cítrico anhidro; L*, a*, b*, Cab* y hab parámetros del sistema CIElab, AMT: microorganismos aerobios mesófilos totales. Valores en la misma fila con diferente letra muestran diferencias estadísticamente significativas (p≤0,05) por variedad.
En las frutillas var. ‘Camarosa’ no se observaron cambios de color en función de las variables de proceso. Los porcentajes de los cambios de color en todos los parámetros (L*, a*, b*, Cab* y hab) no fueron superiores al 13% (Van de Velde et al. 2013). Por el contrario, los parámetros de color en las frutillas var. ‘Selva’ fueron afectados por las tres variables del proceso. La concentración de APA afectó principalmente los parámetros de color L* y Cab* . Se obtuvieron frutillas más claras (mayor L*) que la materia prima al ser lavadas por inmersión con concentraciones de APA superiores a 80 mg/L y tiempos de tratamiento superiores a los 100 s a 22°C. La oxidación y posterior degradación de antocianinas por el APA podrían justificar la obtención de frutas más claras. En cuanto al croma (Cab*), se encontró que en todas las condiciones de lavado se obtuvieron frutillas de color más vívido que la materia prima. Numerosas combinaciones de tiempos de inmersión y concentraciones de APA demuestran la posibilidad de realizar el lavado preservando el tono rojo (hab) característico de
254 desarrollo sostenible
Camarosa Selva AA (mg/100 g) 36,1 ± 2,5b 14,8 ± 0,6a Vit C (mg/100 g) 41,2 ± 3,4b 28,7 ± 0,3a FT (mg AG/100 g) 324,2 ± 6,2b 292,4 ± 5,1a Ant T (mg/100 g) 47,0 ± 2,2b 19,0 ± 0,8a CA (mg AA/100 g) 440,1 ± 8,1b 395,7 ± 7,2a SS (° Brix) 8,5 ±0,1b 6,6 ± 0,2a pH 3,4 ± 0,1a 3,4 ± 0,1a AT (g ACA/100 g) 0,8 ± 0,1a 0,8 ± 0,1a L0 * 30,1 ± 0,1b 32,3 ± 0,6a a0 * 37,2 ± 0,6b 25,4 ± 0,7a b0 * 20,7 ± 0,1b 12,2 ± 0,6a Cab0 * 42,5 ± 0,5b 28,2 ± 0,9a hab0 29,1 ± 0,6b 25,7 ± 0,5a AMT (log UFC/g) 3,8 ± 0,1a 3,6 ± 0,1a
la fruta o volviéndolas aún más rojas. El aumento en el tono rojo en esta área experimental (tiempos mayores de 65 s y concentraciones entre 30 y 70 mg/L) podría justificarse por el bajo pH de las soluciones de APA (pH< 4) que intensifican el tono rojo de las antocianinas (Van de Velde et al. 2013).
Como puede observarse en la Tabla 2, la retención de ácido ascórbico, compuestos fenólicos y antocianinas totales para ambas variedades disminuye a medida que la concentración de APA y el tiempo de inmersión aumentan. La capacidad antioxidante, en cambio, sólo se ve afectada por la concentración de APA utilizada, indicando que una mayor concentración resulta en menor retención de capacidad antioxidante.
Tabla 2. Valores predichos de la retención de ácido ascórbico (RAA), fenoles totales (RFT), antocianinas totales (RAnt T) y capacidad antioxidante (RCA) después del lavado-desinfección por inmersión con ácido peracético (APA) de frutillas frescas cortadas ‘Camarosa’ y ‘Selva’ a 24°C.
En el espacio experimental ensayado por Van de Velde et al. (2013), la mínima y máxima retención de antocianinas totales fue de 54,6 % (obtenido a 100 mg/L, 120 s y 40°C) y 95,9 % (obtenida a 13 mg/L, 10 s y 26°C), respectivamente. Alexandre et al. (2012) determinó un 85 % de retención de antocianinas totales después del lavado con agua de frutillas enteras var. ‘Camarosa’ durante 120 s a 15°C. En lo que respecta al ácido ascórbico, Alexandre et al. (2012) reportó que la máxima retención (98 %) se logra con un lavado de las frutillas enteras sólo con agua, 120 s y 15°C, resultando para éstas mismas condiciones, 83,4 % de retención en frutillas frescas cortadas según lo informado por Van de Velde et al. (2013). Estas diferencias pueden deberse a la mayor superficie expuesta a la solución de lavado de las frutas cortadas.
La menor y mayor retención de compuestos fenólicos fue 84,3 % (68 mg/L APA y 120 s) y 97 % (0 mg/L APA y 10 s), respectivamente. La retención
255 Descontaminación D e frutas finas
APA (mg/L) Tiempo (s) rAA (%) RFT (%) RAnt T (%) rCA (%) 20 20 95,4 93,0 95,1 92,4 60 97,9 90,9 90,1 92,4 120 75,0 87,8 82,6 92,4 40 20 89,4 90,8 92,0 90,0 60 91,9 88,7 87,0 90,0 120 69,0 85,5 79,5 90,0 80 20 77,3 89,8 85,8 85,1 60 79,8 87,7 80,8 85,1 120 56,9 84,5 73,3 85,1
sostenible
de la capacidad antioxidante disminuyó a medida que la concentración de APA aumentó. Como puede verse en la Tabla 2, dicha retención no fue afectada por el tiempo de inmersión ni por la temperatura de la solución de lavado. El mayor y menor valor predicho de la retención de capacidad antioxidante resultó 100 % (0 mg/L) y 77 % (100 mg/L APA), respectivamente.
La retención de vitamina C (ácido ascórbico más ácido deshidroascórbico) de frutillas ‘Camarosa’ cortadas en cuartos, no fue afectada por las diferentes condiciones de las variables de proceso (Van de Velde et al. 2013). Es decir que para todo el dominio experimental ensayado (0-100 mg/L APA, 10-120 s, y 4-40°C), la pérdida promedio de vitamina C fue del 10 ± 4 %. Sin embargo para las frutillas var, ‘Selva’ cortadas en cuartos, la retención de vitamina C resultó función de la concentración de APA y el tiempo de inmersión, La menor retención de vitamina C (67,6 %), en este caso, ocurrió a 100 mg/L APA y 120 s, indicando que más del 30 % se ha degradado a ácido dicetogulónico, perdiendo su poder vitamínico.
En resumen, el efecto oxidante del APA justifica las pérdidas de ácido ascórbico, vitamina C, compuestos fenólicos y de la capacidad antioxidante de las frutillas. Si se estiman las pérdidas en estos compuestos para los valores de concentración de APA (80 mg/L) recomendados por CFR (2018), se obtendría una reducción de antocianinas de aproximadamente el 27 % y 43 % para el ácido ascórbico, cuando se utiliza el mayor tiempo ensayado (120 s) y 24°C con frutillas frescas cortadas en cuartos (Tabla 2).
De acuerdo a los resultados anteriormente mencionados, puede verse que resulta esencial balancear los aspectos favorables del lavado-desinfección (descontaminación microbiológica) con los perjudiciales como son la pérdida de calidad sensorial y potencial saludable de las frutillas.
En este sentido, Van de Velde et al. (2014) empleó la metodología de optimización de respuestas múltiples para determinar las condiciones de lavado por inmersión óptimas con dos objetivos diferentes. Uno de los objetivos (OP1) fue maximizar la reducción microbiológica de AMT limitando una pérdida de no más del 10 % en los compuestos bioactivos (90 % de retención de ácido ascórbico y de antocianinas totales). Para satisfacer estas condiciones, los valores óptimos de las variables del proceso resultantes fueron 100 mg/L de APA, 24°C y 50 s de tiempo de inmersión. El otro objetivo (OP2) fue maximizar la retención los compuestos bioactivos y alcanzar una reducción de 2 log de AMT con respecto a la carga inicial de la materia prima. El proceso debería realizarse aplicando las siguientes condiciones: 20 mg/L de APA, 18°C y 52 s. Posteriormente, se realizaron ensayos de validación para ambas condiciones de optimización, evaluando sensorialmente las frutillas frescas cortadas obtenidas y comparándolas con las muestras control (lavadas con agua durante 2 min) con panel experto (datos no mostrados). No se observaron diferencias significativas en apariencia general, pardeamiento, firmeza, aroma genuino, sabor genuino, sabor ácido y sabor dulce. Los panelistas reportaron
256 desarrollo
una presencia leve de sabores desagradables en las frutillas lavadas en la condición OP1 y presencia leve de olores desagradables en las frutillas lavadas en OP1 y OP2 con respecto a las muestras control. Los autores recomiendan 20 mg/L de APA, 18°C y 52 s como condiciones de proceso para frutillas ‘Camarosa’ cortadas en cuartos debido a la aceptable reducción de la carga microbiológica (rAMT = 0,8 ± 0,4 log), mayor retención de antocianinas y ácido ascórbico (87,2 ± 0,5 % y 93,3 ± 2,0 %, respectivamente), buena calificación de atributos sensoriales y conveniencia económica por menor consumo de APA.
3. L AVADO - DESINFECCIÓN POR ASPERSIÓN
La técnica de aspersión surge como una alternativa a la inmersión y puede considerarse como un buen método de lavado-desinfección de frutas frescas, ya que, además del efecto antimicrobiano del sanitizante, hay una remoción física extra producida por la presión del aspersor (Chang y Schneider 2012). Además, es una tecnología amigable con el ambiente ya que produce menor cantidad de agua residual que las técnicas de inmersión. Sin embargo, existe escasa información sobre el impacto de esta tecnología sobre la calidad de frutas frescas cortadas. Méndez-Galarraga et al. (2018) modelaron y optimizaron el lavado-desinfección por aspersión de frutillas frescas cortadas con APA sobre la calidad microbiológica, nutricional y sensorial. Además, los autores evaluaron la efectividad del método a través de la reducción de un patógeno modelo (Escherichia coli). Para estos objetivos, se planteó un diseño de Metodología de Superficie Respuesta, siendo las variables estudiadas, la concentración del sanitizante (APA: 1 – 240 mg/L) y el tiempo de aspersión (t: 11-138 s).
Para ver el efecto que produce esta tecnología en la microflora nativa, se evaluaron las reducciones microbiológicas de aerobios mesófilos totales (rAMT), mohos (rM) y levaduras (rL) en el día de procesamiento (día 0) y a los 7 días de almacenamiento a 2°C. La concentración de APA tuvo mayor efecto que el tiempo de aspersión sobre las rAMT, rM y rL en el día del procesamiento. A medida que incrementan ambas variables (C y t), incrementa la reducción de todos los microorganismos analizados, excepto para mohos que sólo se ve afectado por la concentración del sanitizante (Tabla 3). Además, luego del almacenamiento refrigerado a 2 °C por 7 días, los recuentos de microorganismos continuaron reduciéndose.
En cuanto a la reducción de E. coli, los autores reportaron que, en el rango experimental ensayado, en las frutas lavadas a altas concentraciones de APA, el tiempo influye positivamente en la respuesta (a mayores tiempos, mayores reducciones), llegando a una reducción predicha de 4 log cuando las condiciones son las extremas: 240 mg/L y 138 s. Después de 7 días de almacenamiento a 2°C, la concentración del sanitizante y el tiempo no afectaron significativamente la rEcoli, obteniéndose una reducción promedio de 2,4 log.
257 Descontaminación D e frutas finas
Tabla 3. Valores predichos de la reducción de aerobios mesófilos totales (rAMT), mohos (rM), levaduras (rL) y Escherichia coli (rEcoli) después del lavado-desinfección por aspersión con ácido peracético (APA) de frutillas frescas cortadas.
Como se muestra en la Figura 1, el recuento de E. coli en el día 7 fue generalmente menor que en el día 0. Según Abadias et al. (2011), la eficacia de los métodos de descontaminación se refleja en la reducción microbiológica obtenida, pero es aún más importante el mantenimiento de esta reducción durante el almacenamiento. Por lo tanto, el lavado-desinfección por aspersión con APA no solo reduce el recuento de E. coli y de la microflora nativa, sino que también previene el incremento de los mismos durante el almacenamiento por 7 días a 2°C. Esto probablemente se deba a la acción germicida residual que tiene el APA.
Por otra parte, Méndez-Galarraga et al. (2018) reportaron que el lavado-desinfección por aspersión no afecta de manera significativa los parámetros de color de las frutillas cortadas en el rango experimental ensayado. La reducción promedio del parámetro de color L* (luminosidad) en este estudio fue de alrededor del 1%, indicando que las frutas lavadas fueron ligeramente más oscuras que las muestras control, y no hubo cambios durante el almacenamiento por 7 días a 2 °C. El color de las frutillas frescas cortadas fue más vívido que las muestras control (aumento de alrededor del 20% de Cab*) y en el almacenamiento este cambio fue significativamente menor. Por último, las muestras lavadas fueron ligeramente menos rojas (aumento de hab de alrededor del 12%) que las muestras control, y este cambio se mantuvo en el almacenamiento. Además, se observó que el lavado-desinfección por aspersión con APA en las frutillas frescas cortadas y su posterior almacenamiento no afectó la retención de sólidos solubles con respecto a las muestras control, aunque la retención del pH fue afectada ligeramente en el almacenamiento (Tabla 4).
258 desarrollo sostenible
APA (mg/L) Tiempo (S) rAMT rM rL rEcoli 20 20 0,1 0,8 0,4 2,1 60 0,4 1,3 1,8 120 0,5 1,3 1,4 80 20 0,6 1,2 0,9 1,8 60 0,8 1,8 2,0 120 1,0 1,8 2,1 200 20 0,8 2,0 1,9 1,3 60 1,1 2,8 2,2 120 1,3 2,8 3,6


Figura 1. Efecto del almacenamiento a 2°C sobre frutillas frescas cortadas inoculadas con E. coli lavadas por aspersión con ácido peracético (APA). R11: muestras tratadas con 1 mg/L 75 s; RCP: promedio de los puntos centrales de las muestras tratadas con 120,5 mg/L y 75 s; R9: muestras tratadas con 120,5 mg/L y 138 s; R2: muestras tratadas con 240 mg/L y 75 s. Diferentes letras sobre las barras indican diferencias significativas (P≤0,05).
Como se describió anteriormente, Van de Velde et al. (2014) maximizaron la retención de ácido ascórbico y antocianinas totales con una reducción razonable de microorganismos (2 log) en el lavado-desinfección de frutillas frescas cortadas por inmersión con 20 mg/L de APA y 52 s. En esas condiciones, las retenciones para antocianinas totales y ácido ascórbico fueron del 87,2 y 93,3 %, respectivamente. Méndez-Galarraga et al., (2018) reportaron que las retenciones de estos compuestos bioactivos en el sistema de lavado por aspersión con APA en las condiciones optimizadas por Van de Velde et al. (2014) fueron menores (~74 % para antocianinas totales y 79 % para ácido ascórbico). Sin embargo, la retención de vitamina C fue de alrededor del 84 %, indicando que hubo una oxidación parcial del L-ácido ascórbico a L-ácido deshidroascórbico debido al APA, pero manteniendo su actividad biológica (Hernández et al. 2006). Paralelamente, en este trabajo hubo una retención importante de la capacidad antioxidante (~98 %), probablemente, debido a la retención lograda en los compuestos fenólicos (~96 %) (Tabla 4).
Empleando la metodología de optimización de respuestas múltiples, Méndez-Galarraga et al. (2018) encontraron que las condiciones óptimas del lavado-desinfección por aspersión de frutillas frescas cortadas para maximizar la reducción de AMT, M y L en el día del procesamiento (día 0) fueron 240 mg/L y 97 s, alcanzándose una reducción de 1,2, 2,4 y 3,3 log, respectivamente.
259 Descontaminación D e frutas finas a a a a b b b b 0 2 4 6 8 r11 rCP r9 r2 Recuento de E. coli ( logCFU /g)
Corrida
Día 0 Día 7
En función de estos resultados, el lavado por aspersión con APA puede considerarse una buena alternativa de desinfección de frutillas frescas cortadas, en donde no se compromete la calidad sensorial y nutricional de las frutas y se logran reducciones microbiológicas apropiadas.
Tabla 4. Promedios de las respuestas en frutillas frescas cortadas después del lavado-desinfección por aspersión con APA en el día 0 y después de 7 días de almacenamiento a 2°C. Atributos (%)
Letras diferentes en la misma fila indican diferencias significativas (P≤0,05). RSSi: retención de sólidos solubles en el día i; RpHi: retención de pH en el día i; δLi*: cambio de luminosidad en el día i; δCabi*: cambio de chroma en el día i; δhabi: cambio de hue en el día i; RFTi: retención de fenoles totales en el día i; RAnt Ti: retención de antocianinas totales en el día i; RCAi: retención de capacidad antioxidante en el día i; RAAi: retención de ácido ascórbico en el día i; RVitCi: retención de vitamina C en el día i, i es el día de análisis, 0 o 7.
4. D ESINFECCIÓN POSTCOSECHA DE FRUTAS FINAS POR NEBULIZACIÓN
La nebulización o la aerosolización es la dispersión de un agente desinfectante como una fina niebla en el aire y su aplicación en los productos. La aplicación de agentes desinfectantes por nebulización puede ser una tecnología promisoria para la sanitización de berries, ya que la manipulación y la generación de humedad en la superficie de las frutas están minimizadas (Oh et al. 2005). Además, la sanitización por nebulización permitiría sortear la limitación que, a veces, enfrentan las operaciones de lavado-desinfección en alcanzar y eliminar patógenos situados en sitios inaccesibles del producto vegetal (Lee et al. 2004), Sin embargo, la desinfección por aerosolización tiene algunas desventajas, tales como la necesidad de equipos más complejos para la genera-
260 desarrollo
sostenible
Tiempo (d) 0 7 rSSi 99,2a 98,4a rpHi 98,4a 100b δLi* -1,2a -1,3a δCabi* 23,6a 11,2b δhabi 12,2a 9,6a RFTi 95,3a 97,1a RAnt Ti 78,8a 79,4a rCAi 98,2a 97,3a rAAi 74,1a 76,5a rVitCi 83,0a 85,5a
ción de la nube gaseosa y que el número de agentes sanitizantes que pueden ser nebulizados es limitado (Oh et al. 2005).
La nebulización de ácido peracético (APA) surge como una opción promisoria para el control de la población microbiana y la extensión de la vida útil de las berries. Es escasa la bibliografía sobre la aplicación de este desinfectante por nebulización. Oh et al. (2005) estudiaron la nebulización de APA sobre hojas de lechuga inoculadas con Escherichia coli O157:H7, Salmonella typhymurium y Listeria monocytogenes durante 10 a 60 min. Los autores reportaron reducciones altas (cerca de 4 ciclos log) en las poblaciones inoculadas a los tiempos máximos. Sin embargo, los resultados sobre el impacto de estos tratamientos en el contenido de los nutrientes y los compuestos bioactivos del material vegetal no fueron reportados. Van de Velde et al. (2016a) modelaron y optimizaron la operación de desinfección de frutillas frescas por nebulización con APA (APA 5 %, H2O2 20 % y agua), procurando alcanzar buenas reducciones microbiológicas sobre la superficie de las frutas, sin afectar su calidad general, contenido de compuestos bioactivos y capacidad antioxidante. Para estudiar la operación de nebulización los autores utilizaron la metodología de Superficie de Respuesta, siendo las dos variables estudiadas la concentración del desinfectante (3,4-116,6 μL APA por L de aire) y el tiempo de tratamiento (5,7-69,3 min). A mayores concentraciones de APA nebulizado y tiempos de tratamiento, mayores fueron las reducciones en los recuentos de microorganismos aerobios mesófilos totales (rAMT) y de levaduras y mohos (rLyM) sobre la superficie de las frutillas luego de la nebulización. Además, los autores reportaron que la rAMT fue, en general, menor después de 7 días de almacenamiento, manteniéndose en buenos niveles de reducción. Sin embargo, las rLyM fueron más altas después de 7 días de almacenamiento, lo que indicaría una acción residual del desinfectante ecológico nebulizado; similarmente a lo reportado por Méndez-Galarraga et al. (2018) para el lavado-desinfección de frutillas frescas cortadas por aspersión. En un trabajo similar, Vardar et al.(2012) realizaron la desinfección de frutillas por nebulización a 750, 1000, 1500 y 2000 μL de H2O2 al 50 %/L de aire, por 60 min. El tratamiento de desinfección a la concentración de nebulización más alta (2000 μ/L) redujo la población de AMT en la superficie de las frutas en 2 log. La predicción de la reducción de AMT usando el sanitizante APA al 5 %, el cual también contiene H2O2 al 20%, a la concentración de nebulizado más alta: 116,6 μL/L por 60 min fue de 3,5 log (Van de Velde et al. 2016a), una reducción 1,5 log más alta que la obtenida por Vardar et al. (2012). De acuerdo a Baldry (1983), el APA es un excelente bactericida y el H2O2 por sí solo es más efectivo como esporicida que como bactericida. Así, sería evidente el mayor poder en la reducción de la carga microbiológica de la combinación de sanitizantes APA/ H2O2 que el empleo de H2O2 únicamente.
Por otra parte, Vaccari (2017) demostró utilizando el mismo diseño experimental de Van de Velde et al. (2016a) que la desinfección de frutillas
261 Descontaminación D e frutas finas
por nebulización utilizando concentraciones intermedias de APA y periodos de tiempo cortos (por ej., 60 µL/L, 30 min) a 20°C logra reducir la población de E. coli ATTC 25922 inoculada sobre la superficie de las frutas en 4 ciclos log y mantener esa reducción luego del almacenamiento refrigerado, como reportado por Méndez-Galarraga et al. (2018) para el lavado-desinfección de frutillas frescas cortadas por aspersión con 240 mg/L APA y 138 s. Estos resultados podrían ser considerados válidos para el patógeno E. coli O157:H7 por las similitudes que presentan estos microorganismos con respecto de sus características de crecimiento, tolerancia al frío, fijación a superficies de productos frescos e inactivación por calor y por antimicrobianos (Kim y Harrison 2016).
En cuanto al impacto que tiene la nebulización de APA en la calidad y el aporte de compuestos bioactivos de las frutillas, Van de Velde et al. (2016a) reportaron que las retenciones de vitamina C, antocianinas totales, fenoles totales y capacidad antioxidante de las frutas nebulizadas resultaron afectadas tanto por la concentración de APA como por el tiempo de tratamiento. El aumento de la magnitud de ambas variables produjo retenciones menores de los compuestos bioactivos. De acuerdo a la predicciones obtenidas trabajando a la máxima concentración de APA nebulizada (116,6 µL/L) y tiempo de tratamiento (69,3 min) pueden lograrse retenciones superiores al 65 % tanto de vitamina C como de fenoles totales y capacidad antioxidante luego de 7 de almacenamiento a 2°C. Sin embargo, estas condiciones de nebulización podrían ocasionar pérdidas de alrededor del 70 % en el contenido de antocianinas totales en las mismas frutas (Van de Velde et al. 2016a). Las antocianinas son los compuestos fenólicos responsables del color de las frutillas y representan la fuente de antioxidantes más importante de la fruta. Son muy inestables y susceptibles a la degradación durante el procesamiento y almacenamiento de vegetales. En un estudio posterior se reportó que el nebulizado de APA provocó oxidaciones de los compuestos fenólicos individuales de las frutillas en diferentes grados, de acuerdo a la naturaleza química de los mismos (Van de Velde et al. 2016b). Como se había observado previamente, las antocianinas individuales fueron los compuestos fenólicos más vulnerables a la oxidación durante el nebulizado con APA, seguido de las proantocianidinas con nivel bajo de polimerización, los derivados del ácido hidroxicinámico y el elagitanino sanguiin H-6 (Van de Velde et al. 2016b). Los autores reportaron que a medida que la concentración de APA y el tiempo de nebulizado se incrementan, las retenciones de las antocianinas individuales disminuyen. Por ejemplo, la retención de las antocianinas cianidin-3-O-glucósido, pelargonidin-3-O-glucóside y pelargonidin-3-O-rutinóside fueron de 6,6, 15,0 y 43,6 %, respectivamente, cuando las frutillas se nebulizaron con 116,6 µL APA/L de aire por 37,5 min. Los efectos oxidantes del APA y el H2O2 sobre las antocianinas y otros compuestos bioactivos de las frutillas fueron descriptos por otros autores (Özkan et al. 2005). Aparentemente, el H2O2, presente en la mezcla sanitizante junto al APA, o sus productos de descomposición son nucleófilos fuertes, los cuales se
262 desarrollo
sostenible
pueden adicionar a la molécula de antocianina produciendo la ruptura de la molécula y/o la formación de chalconas incoloras (Özkan et al. 2005).
Por otra parte, la desinfección por nebulización usando APA fue utilizado por Vaccari (2017) sobre zarzamoras frescas. En este caso, para todas las concentraciones de APA (3,4 - 116,6 μL APA/litro de aire), el tratamiento presentó una capacidad de desinfección de AMT de 2 log tanto para tiempos cortos (5,7 min) como tiempos largos (69,3 min). Además, el aumento de la concentración de APA redujo significativamente los niveles de mohos y levaduras, correspondiendo las máximas reducciones a la concentraciones de APA y tiempos de tratamiento empleados extremos (116,6 μL APA/litro de aire y 69,3 min). Luego del almacenamiento de las zarzamoras a 2°C, estos resultados se mantuvieron o incluso se observaron mayores reducciones de mohos y levaduras, indicando una acción residual del APA en las frutas nebulizadas. Además, el tratamiento de desinfección produjo una reducción muy alta en el recuento de E. coli inoculada, debido al poder sanitizante del APA y a la cutícula protectora cerosa de las zarzamoras, la cual brinda un efecto protector adicional a las frutas, impidiendo la correcta adherencia de los microorganismos (Vaccari 2017). En cuanto a la calidad sensorial, la aplicación de APA por nebulización no produjo cambios importantes, aunque las zarzamoras nebulizadas resultaron menos azules, posiblemente por oxidación de antocianinas coloreadas. En ese sentido, se encontró que la nebulización de APA en ciertas concentraciones y tiempos provocó pérdidas considerables en el potencial bioactivo de las zarzamoras. Los flavonoides del tipo antocianinas, los cuales representan cerca del 80 % del total de los compuestos fenólicos en zarzamoras, resultaron afectados por algunas de las condiciones del tratamiento.
Si bien la nebulización del APA demostró ser efectiva para controlar la carga microbiológica nativa e inoculada de las frutas tratadas, las propiedades oxidantes del desinfectante en algunas condiciones evidenciaron pérdidas de la calidad sensorial y del potencial bioactivo de las mismas. Por lo tanto, el empleo de la metodología de optimización de respuestas múltiples permitió determinar las condiciones de desinfección óptimas para maximizar la reducción microbiológica y minimizar los cambios sensoriales y pérdidas en el potencial bioactivo de las frutas. Para el caso de las frutillas, por ejemplo, el tratamiento de desinfección por nebulización a las condiciones óptimas 10,1 µL/L por 29,6 min logra reducciones de ~ 1 log en AMT y LyM, con una retención de los compuestos bioactivos del 92 %, y sin cambios en el color de las frutas. Además, las frutillas nebulizadas en esas condiciones, almacenadas a 2 °C por 7 días tuvieron reducciones microbiológicas apropiadas (de ~ 1,3 log en AMT y LyM), buena retención de compuestos bioactivos y estabilidad del color.
En conclusión, la nebulización de frutas finas (frutillas y zarzamoras) utilizando el desinfectante ecológico APA sería una opción promisoria para extender la vida postcosecha de estas frutas sin comprometer su apariencia general ni su valioso aporte en compuestos bioactivos.
263 Descontaminación D e frutas finas
CONSIDErACIONES FINALES
En este capítulo se abordó la problemática del lavado-desinfección de frutillas mínimamente procesadas usando el sanitizante ecológico APA por inmersión y aspersión. Además se estudió la desinfección postcosecha de frutillas y zarzamoras enteras por nebulización. La inmersión y la aspersión de frutillas mínimamente procesadas con soluciones de APA produce una buena descontaminación microbiológica, pero ciertas condiciones resultan perjudiciales sobre la calidad sensorial y potencial saludable de las frutas. Esto demuestra la necesidad de optimizar el proceso. Las concentraciones óptimas obtenidas en la inmersión y la aspersión de frutillas mínimamente procesadas resultan superiores a la autorizada (80 mg/L) cuando se maximiza la reducción microbiológica e inferiores cuando se prioriza la retención de compuestos bioactivos y calidad sensorial.
Por otra parte, la nebulización de APA demostró ser una opción promisoria para extender la vida postcosecha de frutillas y zarzamoras sin comprometer su calidad sensorial ni su valioso aporte en compuestos bioactivos. El APA resulta una opción ecológica para la descontaminación de frutas enteras y mínimamente procesadas, el cual presenta, además, un efecto residual sobre la carga microbiológica luego de 7 días de almacenamiento refrigerado.
R EFERENCIAS BIBLIOGRÁFICAS
[CFR] C of FR (2018) Online reference included in secondary direct food additives permitted in food for human consumption: Chemicals used in washing or to assist in the peeling of fruits and vegetables. Chlorine dioxide. https://www.accessdata.fda.gov/scripts/cdrh/cfdocs/cfcfr/cfrsearch.cfm?fr=173.315. Acceso Junio 2019.
Abadias M, Alegre I, Usall J et al (2011) Evaluation of alternative sanitizers to chlorine disinfection for reducing foodborne pathogens in fresh-cut apple. Postharvest Biology and Technology, 59:289–297. doi:10.1016/j.postharvbio.2010.09.014
Alexandre EMC, Brandão TRS, Silva CLM (2012) Efficacy of non-thermal technologies and sanitizer solutions on microbial load reduction and quality retention of strawberries. Journal of Food Engineering, 108:417–426.
Baldry MGC (1983) The bactericidal, fungicidal and sporicidal properties of hydrogen peroxide and peracetic acid. Journal of Applied Microbiology, 54:417–423. doi:10.1111/j.1365-2672.1983.tb02637.x
Beuchat LR, Adler B, Lang M (2004) Efficacy of chlorine and a peroxyacetic acid sanitizer in killing Listeria monocytogenes on Iceberg and Romaine Lettuce using simulated commercial processing conditions. Journal of Food Protection, 67:1238–1242. doi:10.4315/0362-028x-67.6.1238
Chaidez C, Campo NC, Heredia JB, et al. (2012) Chlorine. En: Decontamination of Fresh and Minimally Processed Produce. Wiley-Blackwell, Hoboken, Nueva Jersey, Estados Unidos, pp. 121-133
264 desarrollo sostenible
Chang AS, Schneider KR (2012) Evaluation of overhead spray-applied sanitizers for the reduction of salmonella on tomato surfaces. International Journal of Food Science, 77: 65-69. doi:10.1111/j.1750-3841.2011.02486.x
Gómez Riera P, Bruzone I, Kirschbaum D (2013) Visión prospectiva de la cadena de frutas finas al 2030. 1ed. Ministerio de Ciencia, Tecnología e Innovación Productiva, Buenos Aires, Argentina, 184p.
Hernández Y, Lobo MG, González M (2006) Determination of vitamin C in tropical fruits: A comparative evaluation of methods. Food Chemitry, 96:654–664. doi:10.1016/j.foodchem.2005.04.012
Jung H, Lee HJ, Cho H, et al (2015) Anthocyanins in Rubus fruits and antioxidant and anti-inflammatory activities in RAW 264.7 cells. Food Science and Biotechnology, 24:1879–1886. doi: 10.1007/s10068-015-0246-1
Kim H, Ryu J-H, Beuchat LR (2006) Survival of Enterobacter sakazakii on fresh produce as affected by temperature, and effectiveness of sanitizers for its elimination. International Journal of Food Science, 111:134–143. doi:10.1016/J.IJFOODMICRO.2006.05.021
Kim JK, Harrison MA (2016) Surrogate selection for Escherichia coli O157:H7 based on cryotolerance and attachment to Romaine lettuce. ournal of Food Protection, 72:1385–1391. doi:10.4315/0362-028x-72.7.1385
Kitis M (2004) Disinfection of wastewater with peracetic acid: a review. Environment International, 30:47–55. doi:10.1016/S0160-4120(03)00147-8
Kunigk L, Almeida MCB (2001) Action of peracetic acid on Escherichia coli and Staphylococcus aureus in suspension or settled on stainless steel surfaces. Brazilian Journal of Microbiology, 32:38–41.
Lee SY, Costello M, Kang DH (2004) Efficacy of chlorine dioxide gas as a sanitizer of lettuce leaves. Journal of Food Protection, 67:1371–1376.
Lee W-N, Huang C-H (2019) Formation of disinfection byproducts in wash water and lettuce by washing with sodium hypochlorite and peracetic acid sanitizers. Food Chemistry, 1:1-17. doi:10.1016/J.FOCHX.2018.100003
Lynch MF, Tauxe RV, Hedberg CW (2009) The growing burden of foodborne outbreaks due to contaminated fresh produce: risks and opportunities. Epidemiology & Infection, 137:307–315.
Méndez-Galarraga MP, Salsi MS, Piagentini AM, Pirovani ME (2018) Spray washing disinfection with peracetic acid in the processing of fresh-cut strawberries: An alternative for dipping techniques. International Journal of Fruit Science, 3:258-275. doi:10.1080/15538362.2018.1502722
Oh SW, Gray PM, Dougherty RH, Kang DH (2005) Aerosolization as novel sanitizer delivery system to reduce food-borne pathogens. Letters in Applied Microbiology, 41:56–60. doi:10.1111/j.1472-765X.2005.01711.x
Özkan M, Yemenicioğlu A, Cemeroğlu B (2005) Degradation of various fruit juice anthocyanins by hydrogen peroxide. Food Research International 38:1015–1021. doi:10.1016/J.FOODRES.2005.03.013
Pechacek N, Osorio M, Caudill J, Peterson B (2015) Evaluation of the toxicity data for peracetic acid in deriving occupational exposure limits: A minireview. Toxicology Letters, 233:45–57. doi:10.1016/J.TOXLET.2014.12.014
Pirovani ME, Güemes DE, Piagentini AM (2006) Vegetales frescos cortados. Procesamiento y calidad. Ediciones UNL, Santa Fe, Argentina, 92p.
265 Descontaminación D e frutas finas
Ramos B, Miller FAA, Brandão TRSRS et al (2013) Fresh fruits and vegetables - An overview on applied methodologies to improve its quality and safety. Innovative Food Science and Emerging Technologies, 20:1–15.
Sapers GM (2001) Efficacy of washing and sanitizing methods for disinfection of fresh fruit and vegetable products. Food Technology and Biotechnology, 39:305–311.
Silveira AC, Conesa A, Aguayo E, Artes F (2008) Alternative sanitizers to chlorine for use on fresh-cut “Galia” (Cucumis melo var. catalupensis) melon. International Journal of Food Science, 73:M405–M411.
Vaccari MC (2017) Desinfección de frutillas y zarzamoras frescas por nebulización con ácido peracético. Tesis de Maestía en Ciencia y Tecnología de Alimentos, Universidad Nacional del Litoral
Van de Velde F, Grace MH, Pirovani MT, Lila MA (2016b) Impact of a new postharvest disinfection method based on peracetic acid fogging on the phenolic profile of strawberries. Postharvest Biology and Technology, 117:197205. doi: 10.1016/j.postharvbio.2016.03.005
Van de Velde F, Güemes DR, Pirovani ME (2014) Optimisation of the peracetic acid washing disinfection of fresh-cut strawberries based on microbial load reduction and bioactive compounds retention. International Journal of Food Science & Technology, 49:634–640. doi:10.1111/ijfs.12346
Van de Velde F, Piagentini AM, Güemes DR, Pirovani ME (2013) Modelling changes in anthocyanins, total vitamin C and colour as a consequence of peracetic acid washing disinfection of two cultivars of strawberries for fresh-cut processing. International Journal of Food Science & Technology, 48:954–961. doi:10.1111/ijfs.12047
Van de Velde F, Tavella A, Piagentini AM, et al (2010) Retención De Compuestos Bioactivos En El Lavado-Desinfección De Frutillas Mínimamente Procesadas Con Ácido Peracético. Revista Iberoamericana de Tecnología Postcosecha, 18: 162–169.
Van de Velde F, Vaccari MC, Piagentini AM, Pirovani ME (2016a) Optimization of strawberry disinfection by fogging of a mixture of peracetic acid and hydrogen peroxide based on microbial reduction, color and phytochemicals retention. Food Science and Technology International, 22:485–495. doi:10.1177/1082013215625696
Vandekinderen I, Devlieghere F, Van Camp J, et al (2009) Impact of a decontamination step with peroxyacetic acid on the shelf-life, sensory quality and nutrient content of grated carrots packed under equilibrium modified atmosphere and stored at 7°C. Postharvest Biology and Technology, 54:141–152. doi:10.1016/J.POSTHARVBIO.2009.06.007
Vandekinderen I, Van Camp J, Devlieghere F et al. (2008) Effect of decontamination agents on the microbial population, sensorial quality, and nutrient content of grated carrots (Daucus carota L.). Journal of Agricultural and Food Chemistry, 56:5723–5731. doi:10.1021/jf800681a
Vardar C, Ilhan K, Karabulut OA (2012) The application of various disinfectants by fogging for decreasing postharvest diseases of strawberry. Postharvest Biology and Technology, 66:30–34. doi:10.1016/j.postharvbio.2011.11.008
266 desarrollo sostenible
16
INOCUIDAD ALIMENTARIA: UNA NECESIDAD CAMINO A LA SUSTENTABILIDAD
Laura Mereles1 & Eleuterio Umpiérrez2
1 Universidad Nacional de Asunción (UNA), Facultad de Ciencias Químicas, Dpto. Bioquímica de Alimentos, Km. 11 Campus Universitario San Lorenzo, Paraguay, C.P. 1055. E-mail: lauramereles@qui.una.py
2 Universidad de la República (UdelaR), Facultad de Química, Instituto Polo Tecnológico de Pando, Pass Ruta 101 y Ruta 8 s/n, esquina Aparicio Saravia, Pando, CP 91000, Uruguay. E-mail: eumpierr@fq.edu.uy
INTRODUCCIÓN
Una población mundial de 7,6 billones que se espera que alcance los 8,6 billones en 2030 y los 9,8 billones en 2050 requerirá un aumento en la producción total de alimentos para respaldar una demanda creciente por parte de los consumidores con alimentos de calidad y altamente nutricionales, en particular en economías emergentes (Bouzembrak y Marvin 2019). Tomando en cuenta estos desafíos, en septiembre de 2015 los 193 Estados miembros de Naciones Unidas establecieron la Agenda 2030 para el Desarrollo Sostenible, que da continuidad a los Objetivos de Desarrollo del Milenio (ODM).
La Agenda 2030, que entró en vigencia en enero de 2016, contempla un conjunto de 17 Objetivos de Desarrollo Sostenible (ODS) que implican los objetivos mundiales para el desarrollo del Mundo y que contienen 169 metas que deberán guiar las acciones de los gobiernos, los organismos internacionales, la sociedad civil y otras instituciones en los próximos 15 años (2016-2030). A través de estos ODS y las metas planteadas en la Agenda 2030 se integran las tres dimensiones del desarrollo sostenible (económico, social y ambiental). Adicionalmente, la seguridad alimentaria y nutricional tiene relación directa o indirecta con los 16 ODS restantes. El objetivo 2 (Hambre cero) establece en forma global que “Los Objetivos de Desarrollo Sostenible buscan terminar con todas las formas de hambre y desnutrición para 2030 y velar por el acceso de todas las personas, en especial los niños, a una alimentación suficiente y nutritiva durante todo el año. Esta tarea implica promover prácticas agrícolas sostenibles a través del apoyo a los pequeños agricultores y el acceso igualitario a la tierra, la tecnología y los mercados. Además, se requiere el fomento de la cooperación internacional para asegurar la inversión en la infraestructura y la tecnología necesaria para mejorar la productividad agrícola” (PNUD 2019). En la Figura 1 se resumen los planteamientos del ODS2.
Stadnik MJ, Velho AC, Zorrilla SE (eds.) Desarrollo Sostenible en la Producción Agroalimentaria
267

FIN AL HAMBrE

SEGurIDAD ALIMENTARIA

ODS 2

MEjORA DE LA NUTRICIÓN


PrOMOVEr AGRICULTURA SOSTENIBLE


Figura 1. Planteamientos de los objetivos del Desarrollo Sostenible (ODS2) (Adaptado de PNUD 2019).
Para ello, las metas propuestas para el 2030 en aras al cumplimiento de este objetivo son:
• META 3: duplicar la productividad agrícola y los ingresos de los productores de alimentos en pequeña escala, en particular de las mujeres, los pueblos indígenas, los agricultores familiares, los pastores y los pescadores, entre otras cosas mediante un acceso seguro y equitativo a las tierras, a otros recursos de producción e insumos, conocimientos, servicios financieros, mercados y oportunidades para la generación de valor añadido y empleos no agrícolas;
• META 4: asegurar la sostenibilidad de los sistemas de producción de alimentos y aplicar prácticas agrícolas resilientes que aumenten la productividad y la producción, contribuyan al mantenimiento de los ecosistemas, fortalezcan la capacidad de adaptación al cambio climático, los fenómenos meteorológicos extremos, las sequías, las inundaciones y otros desastres, y mejoren progresivamente la calidad del suelo y la tierra.
Sin embargo, a pesar del creciente reconocimiento del papel fundamental que desempeña la inocuidad de los alimentos en el logro de los Objetivos de Desarrollo Sostenible (ODS) y los principales objetivos del Decenio de las Naciones Unidas de Acción sobre la Nutrición, los esfuerzos por fortalecer los sistemas de inocuidad de los alimentos siguen fragmentados, y los beneficios han estado muy por debajo de las expectativas, particularmente en muchos países en desarrollo (WHO 2019). Esto indica que para lograr el ODS2 el
268 desarrollo sostenible
acceso a alimentos inocuos, nutritivos y suficientes se debe considerar un derecho humano, dando prioridad a las personas más vulnerables. Se requieren políticas que promuevan la agricultura y los sistemas alimentarios que tengan en cuenta la nutrición, prestando especial atención a la seguridad alimentaria y la nutrición de los niños menores de 5 años, los niños en edad escolar, las adolescentes y las mujeres (FAO, FIDA, UNICEF, PMA y OMS 2018).
1. SISTEMAS ALIMENTARIOS y SUSTENTABILIDAD
Los cambios en el clima, la producción mundial de alimentos y los sistemas de suministro afectan a los consumidores, a la industria y al planeta en sí mismo. La carga que suponen los alimentos insalubres afecta de forma desproporcionada a las personas vulnerables y marginadas y plantea desafíos en materia de sostenibilidad y desarrollo (FAO 2017). Los desafíos globales de hoy están transformando la forma en que producimos, comercializamos, consumimos y pensamos acerca de los alimentos (Robinson et al. 2019). La región no está exenta de los impactos de la globalización, la urbanización y el cambio climático. Esto se evidencia en ciertos procesos relacionados con la producción y consumo de alimentos, lo cual ha significado un aumento en la presión sobre los recursos naturales y la biodiversidad, la concentración de mayores superficies de tierra y canales de comercialización, el desplazamiento o sustitución de los hábitos alimentarios tradicionales y la exclusión de todos aquellos que no logran alcanzar los estándares requeridos. Es necesario promover la transformación de los sistemas alimentarios de la región, reconociendo la particularidad sociocultural y económica de cada uno de los 33 países que la conforman (FAO 2017).
Las enfermedades transmitidas por alimentos (ETAs) llegan anualmente a 600 millones de casos, por lo cual la falta de seguridad/inocuidad en los alimentos, constituye un riesgo mundial para la salud humana y una amenaza para la economía. Los cambios en el clima, la producción mundial de alimentos y los sistemas de suministro afectan a los consumidores, a la industria y al planeta en sí mismo, los sistemas de inocuidad de los alimentos deben seguir el ritmo de estos cambios. La carga que suponen los alimentos insalubres afecta de forma desproporcionada a las personas vulnerables y marginadas y plantea desafíos en materia de sostenibilidad y desarrollo (WHO 2019).
Por su parte, América Latina y el Caribe (ALC) pretende lograr ser una región “Hambre Cero” en concordancia con los ODS. Los índices de producción y de comercio, además de una variedad de plataformas de integración y cooperación, revelan una región que lucha por superar sus dificultades de manera coordinada y multisectorial. A nivel regional, los países han fijado grandes compromisos para erradicar el hambre en todas sus formas, lo cual se refleja en el Plan de Seguridad Alimentaria, Nutrición y Erradicación del Hambre 2025 de la Comunidad de Estados Latinoamericanos y Caribeños (CELAC). Actores de
269 Inocu I dad al I mentar I a
todos los sectores coinciden en orientar los esfuerzos hacia la sostenibilidad de los sistemas alimentarios, como una de las condiciones necesarias para garantizar la seguridad alimentaria y nutricional a lo largo del tiempo (FAO 2017).
Estos avances responden a un compromiso político de los países por generar procesos más sostenibles desde un abordaje holístico de los problemas que aún afectan a la región. Sin embargo, los avances observados en los últimos años pueden verse comprometidos por una serie de elementos estructurales, tales como:
• El uso no sostenible de los recursos naturales;
• Las pérdidas y desperdicios de alimentos;
• La prevalencia de desastres naturales;
• La falta de inocuidad de alimentos de producción local y sistemas de monitoreo eficientes.
Nuestro sistema de alimentación actual en América Latina puede mejorar significativamente si se logran las metas actuales de sustentabilidad en los alimentos considerando estos elementos. Un sistema alimentario es la suma de los diversos elementos, actividades y actores que, mediante sus interrelaciones, hacen posible la producción, transformación, distribución y consumo de alimentos. Cabe resaltar que durante las transformaciones, transacciones e interacciones producidas en el sistema alimentario, puede identificarse una serie de actividades interrelacionadas, a las cuales se va añadiendo o disminuyendo valor sucesivamente, desde la gestión de los recursos naturales y la biodiversidad hasta la gestión de las pérdidas y desperdicios de alimentos (FAO 2017).
“Se propone avanzar hacia un enfoque de sostenibilidad de los sistemas alimentarios, en términos de mejorar su eficiencia e inclusividad como primer paso, tomando como horizonte la idea de que un sistema alimentario sostenible es aquel que garantiza la seguridad alimentaria y nutricional de ésta y las futuras generaciones” (FAO 2017).
De todos los elementos estructurales citados anteriormente, el cambio climático es quizás el más relacionado intrínsecamente con la producción de alimentos y la seguridad alimentaria. Un clima cambiante seguirá aumentando la presión sobre los ecosistemas agrícolas, en particular para las regiones y poblaciones vulnerables. El cambio climático ha demostrado su impacto sobre la producción de alimentos ya sea en forma de sequías, inundaciones o huracanes, afectando a todos los niveles de producción de alimentos de manera sustentable. Por otra parte el cambio climático agudiza la pobreza y puede ocasionar repercusiones negativas en la seguridad alimentaria.
Es decir, los efectos negativos del cambio climático se vinculan con las 4 dimensiones de la seguridad alimentaria que son:
• Disponibilidad: afectación a los niveles de producción de alimentos de producción local nacional, el acceso a los recursos hídricos, la capacidad de importación del país y los stocks de alimentos existentes. Las
270 desarrollo
sostenible
alteraciones climáticas además pueden transformar el desempeño de los sistemas agroalimentarios;
• Acceso: donde influyen diversos factores como el desarrollo demográfico, la desigualdad de género y la variación en los ingresos económicos que perciben las familias, en especial las del sector agropecuari;
• Utilización biológica: la dieta de una población puede verse afectada por alteraciones en la disponibilidad de alimentos, los ingresos de los hogares y el precio de los alimentos, con las repercusiones conocidas como carencias por una oferta e ingesta alimentaria poco variada y alejada de patrones alimentarios saludables. Como ejemplo, hay aproximadamente 2 billones de personas en el mundo que sufren de deficiencias de micronutrientes. El ácido fítico es la forma de almacenamiento de fósforo en las plantas y se encuentra en altas concentraciones en semillas, cereales y legumbres, como los humanos no pueden digerir o fraccionlo en el intestino y debido a su alta capacidad de unión a minerales, se lo clasifica como un antinutriente. Este es uno de los elementos importantes que deben considerarse al determinar la biodisponibilidad del zinc y el hierro de diferentes dietas a base de alimentos vegetales, claves dentro del marco de seguridad alimentaria, en periodos de escasez de alimentos y los niveles de ingesta dietética requeridos (Dahdouh et al. 2018). Se estima que 17,3% de la población mundial está en riesgo de una ingesta inadecuada de zinc, mientras que casi el 30% es anémico, muchos debido a la deficiencia de hierro (OMS, 2013) y es por ello que las deficiencias de zinc y hierro constituyen un problema de salud pública importante (Dahdouh et al. 2018);
• Estabilidad: los efectos del cambio climático influyen directamente en la dimensión de la estabilidad de alimentos disponibles accesibles y utilizables biológicamente para la nutrición, ya que genera incertidumbre respecto al desempeño productivo de las actividades agrícolas, de los ingresos de los hogares y los precios (Rapallo 2018).
Paralelamente a los ODS, y como respuesta al cambio climático, a nivel mundial se establecieron compromisos internacionales que manifiestan la importancia de promover soluciones consistentes a los problemas del desarrollo sostenible. Entre los acuerdos internacionales más relevantes se citan:
• Convenio de Diversidad Biológica (CDB);
• Convención sobre el comercio internacional de especies amenazadas de fauna y flora silvestres;
• Convenio sobre el derecho del mar;
• Declaración de principios de manejo sustentable de los bosques y otros delineamientos establecidos en la Conferencia de las Naciones Unidas sobre el medio ambiente y el desarrollo;
• Conferencia Regional de la Convención marco de las Naciones Unidas sobre el cambio climático.
271 Inocu I dad al I mentar I a
La comunidad internacional confirmó la voluntad de afrontar el cambio climático en el Acuerdo de París, en el cual los 197 países que participaron en la Conferencia de las Naciones Unidas sobre el Cambio Climático 2015, conocida como COP 21.
Ahora bien, la transformación de los sistemas alimentarios en los últimos 20 años ha generado también un cambio sobre las expectativas de los consumidores en relación con la inocuidad alimentaria, la nutrición y la salud, ha cambiado la forma en la cual los alimentos se producen, distribuyen, comercializan y consumen, esto es una consecuencia de la globalización, los procesos de urbanización, el desarrollo tecnológico, la apertura de los mercados internacionales y la liberación del comercio (FAO 2017). Sin embargo, en ALC el nivel de los precios de los alimentos se ha mantenido estable pero se ha estancado la disminución de la desigualdad y la pobreza, lo que indica la necesidad de analizar los costos de una dieta saludable, frente a la oferta de alimentos ultraprocesados y muy densos en calorías.
Considerando que la oferta de azúcares y grasas es alta en la región, es decir, son grupos alimenticios a los que la población puede acceder más fácilmente desde el punto de vista de la oferta y de los costos, incluyendo en este grupo también a las golosinas, la manteca y los aceites y grasas animales, en general existe una relación inversa entre el costo calórico promedio (precio por cada 100 calorías) y la concentración calórica (cantidad de calorías por cada 100 g). Las verduras presentan costos de USD 0,80 por cada 100 g de producto. Si bien las verduras presentan un costo calórico alto en comparación a los demás grupos, esto se debe a que se necesita gran cantidad de ellas para completar 100 calorías, pues su aporte energético por cada 100 g es muy bajo. Sin embargo no se necesitan grandes cantidades de verduras para obtener valores significativos de micronutrientes que son indispensables en una dieta sana.
Para mejorar la seguridad alimentaria de la región de manera sustentable es vital mejorar la eficiencia de los procesos y en especial la inclusividad de todos los actores, generando resultados y beneficios más equitativos. Para ello se requiere fortalecer los sistemas alimentarios.
Se puede considerar que un sistema alimentario sostenible abarca una serie de cuestiones como la seguridad del suministro de alimentos, la salud, la asequibilidad, la calidad, una industria alimentaria sólida en términos de empleo y crecimiento y al mismo tiempo, sustentabilidad en términos del cambio climático, la biodiversidad, el agua y la calidad del suelo. La sustentabilidad implica el uso de recursos a tasas que no exceden la capacidad de la Tierra para reemplazarlas. El 40% de las tierras degradadas del mundo están en zonas con elevadas tasas de pobreza, donde los más pobres tienen menos acceso a tierras y agua, y están en una trampa de pobreza de pequeñas explotaciones con suelos de mala calidad y alta vulnerabilidad a la degradación de las tierras y la incertidumbre climática. Los países de la región tienen una gran presión para producir alimentos con alto valor nutricional, provocando la paradoja interna
272 desarrollo sostenible
de exportar alimentos saludables e importar alimentos procesados (FAO 2017). En este contexto para el fortalecimiento de un sistema alimentario sustentable se debe cumplir con tres factores; eficiencia, inclusión y sostenibilidad.
Eficiencia: un sistema alimentario debe ser eficiente en términos biológicos, económicos y ambientales (FAO 2017). Para ello es necesaria la aplicación de estándares fito y zoosanitarios así como programas de monitoreo que aseguren la inocuidad y calidad de los alimentos. Lo que podrá lograrse con el fomento de: a) cultivos agrícolas orientados a la nutrición, aplicando normativas (Codex, ISO, etc.) que aseguren la calidad e inocuidad de los alimentos, b) buenos hábitos alimentarios, c) buenas prácticas de comercialización y d) disminución de las pérdidas y desperdicios. El aumento de la productividad agrícola sigue siendo uno de los medios eficaces para reducir el hambre y la inseguridad alimentaria. Los aumentos de productividad permiten obtener una cantidad mayor de alimentos con los mismos recursos, aumentar los salarios de los agricultores y contribuir a la reducción de precios, beneficiando a los consumidores. Al aumentar la disponibilidad y contribuir a un mejor acceso a los alimentos hay una mejora en las dietas de la población (FAO 2013).
Inclusión: los grupos vulnerables como los niños, mujeres y ancianos suelen ser los más excluidos en América Latina y el Caribe (ALC) y por ello con mayor riesgo de inseguridad alimentaria con malnutrición. A nivel mundial, se estima que cerca del 13% del total de la población está subalimentada. Uno de los segmentos poblacionales más afectados por el hambre es el de los niños. La desnutrición provoca el 45% de la muerte de niños menores a 5 años y se estima que casi 151 millones de niños menores de cinco años de todo el mundo, o más del 22%, estaban afectados por retraso del crecimiento en 2017. Hoy se estima que aún existen alrededor de 821 millones de personas que no disponen de alimentos suficientes para llevar una vida sana y saludable, lo que representa que 1 de cada 9 personas del mundo, no tiene suficiente acceso a alimentos. La gran mayoría de personas que padecen hambre se encuentra en países en desarrollo (FAO y OPS 2017, Rapallo 2018).
Sostenibilidad: para lograr sistemas alimentarios sostenibles es preciso el uso eficiente de los recursos naturales para la producción y la protección de los medio de vida rurales. El sector productivo agropecuario es fundamental para la seguridad alimentaria y nutricional, ya que es la principal fuente de la oferta alimentaria de un país para garantizar la sostenibilidad de alimentos. En la región se producen alimentos suficientes para alimentar a toda su población. Sin embargo, esta situación no garantiza que todos los habitantes tengan asegurado el acceso a alimentos en cantidad y calidad para mantener una dieta variada y nutritiva. En América Latina y el Caribe la producción de alimentos ha crecido más rápido que la población, lo que permitió que la producción per cápita de alimentos se incrementase en un 25% entre 2001 y 2011. Al medir la disponibilidad en términos calóricos, los resultados indican que la capacidad productiva de la región le permite disponer de alimentos más
273 Inocu I dad al I mentar I a
que suficientes para alimentar a toda su población, con un promedio que supera las 3.000 calorías por día por persona. En este sentido, si bien las tendencias del valor de la producción agrícola en la región son positivas, existe todavía un amplio espacio para mejorar la productividad y contribuir fuertemente a la seguridad alimentaria y nutricional a nivel regional y global (FAO y OPS 2017). En términos absolutos, la región ALC cuenta con una producción agrícola suficiente para abastecer los requerimientos nutricionales (FAO 2013), y en términos de aporte de la producción regional al total de la producción de alimentos del mundo, la región realiza una contribución importante en: soja con casi la mitad de la producción global, azúcar con un aporte del 36% del total, y carne bovina con el 26%. La contribución de la región en materia productiva y comercial está influenciada por Sudamérica, dado el tamaño de su economía, superficie y población. La heterogeneidad de la región, queda en evidencia al analizar las exportaciones e importaciones, en el caso de Sudamérica prácticamente en todos los productos (con excepción de trigo y legumbres) las exportaciones superan a las importaciones. En cuanto a Centroamérica y el Caribe, la oferta alimentaria presenta una fuerte dependencia de las importaciones de cereales, soja, carne, entre otros. Cabe destacar la importancia de la agricultura familiar, ya que esta actividad genera entre el 57 y 77% del empleo agrícola, ocupa más del 80% de las explotaciones agrícolas, y produce entre el 27 y 67% de los alimentos de la región (FAO y OPS 2017, Rapallo 2018, Robinson 2019).
2. INOCUIDAD DE ALIMENTOS: FACTOR CLAVE PARA LA SEGURIDAD ALIMENTARIA
Una vez que los sistemas alimentarios sean eficientes, accesibles y sostenibles en términos de producción, para lograr la Seguridad alimentaria, la cual se consigue cuando “a nivel de individuo, hogar, nación y global, todas las personas, en todo momento, tienen acceso físico y económico a suficiente alimento, seguro y nutritivo, para satisfacer sus necesidades alimenticias y sus preferencias, con el objeto de llevar una vida activa y sana”, es vital establecer sistemas de aseguramiento de su inocuidad.
Inocuidad alimentaria de acuerdo a FAO es:“La inocuidad de los alimentos es la ausencia, o niveles seguros y aceptables, de peligro en los alimentos que pueden dañar la salud de los consumidores. Los peligros transmitidos por los alimentos pueden ser de naturaleza microbiológica, química o física y con frecuencia son invisibles a simple vista, bacterias, virus o residuos de pesticidas son algunos ejemplos. La inocuidad de los alimentos tiene un papel fundamental para garantizar alimentos seguros en cada etapa de la cadena alimentaria, desde la producción hasta la cosecha, el procesamiento, el almacenamiento, la distribución, hasta la preparación y el consumo” (FAO 2019).
Se refiere a todos aquellos riesgos asociados a la alimentación que pueden incidir en la salud de las personas, tanto riesgos naturales, como origi-
274 desarrollo sostenible
nados por contaminaciones, por incidencia de patógenos, o bien que puedan incrementar el riesgo de enfermedades crónicas como cáncer, enfermedades cardiovasculares y otras. Como ya se ha mencionado, la inocuidad es una condición necesaria para que haya seguridad alimentaria, pero es un solo aspecto de la misma, puesto que no valdría de nada tener alimentos inocuos si no existen en cantidad suficiente o si la población no tiene acceso a los mismos (INCAP 2011).
Si analizamos el concepto mismo de la Seguridad Alimentaria, donde el uso sostenible de los recursos naturales, las pérdidas y desperdicios y la prevalencia de desastres naturales como efectos del cambio climático afectan a la dimensión de “accesibilidad” , la inocuidad de los alimentos se refiere a la falta de seguridad en su consumo, ya sea debido a la presencia de; a) factores antinutrientes que disminuyen la biodisponibilidad de nutrientes y representan un peligro potencial de malnutrición por déficit en una dieta inadecuada, b) tóxicos per-se como residuos de plaguicidas, residuos de medicamentos de uso veterinario, aditivos no seguros, toxinas de organismos vegetales o animales, compuestos tóxicos generados durante el procesamiento de alimentos, contaminantes ambientales, y contaminantes emergentes. De esto se deduce que la inocuidad alimentaria es un factor fundamental para la seguridad alimentaria de manera sustentable.
La presencia de antinutrientes en alimentos se ha logrado disminuir gracias al conocimiento de la composición de los alimentos y el desarrollo de técnicas culinarias apropiadas y transferidas a través de la sabiduría popular de muchos pueblos para, por ejemplo, la inactivación de inhibidores enzimáticos, eliminación de oxalatos y fitatos, y aquellos con actividad particular como las hemaglutininas, y otros compuestos bociógenos.
Por otro lado, los tóxicos per-se como los residuos de plaguicidas y medicamentos de uso veterinario, las toxinas, contaminantes ambientales o aditivos con potencial efecto sobre la salud como nitritos y edulcorantes artificiales, son evaluados por estudios toxicológicos que han servido de base científica para el conocimiento de alimentos que pueden representar un riesgo para la salud de los consumidores.
En materia de aditivos alimentarios, se han establecido mecanismos para el establecimiento de factores de seguridad como la Ingesta Diaria Admisible (IDA) y protocolos de estudios de seguridad por diferentes ensayos in vitro e in vivo de aquellos con efectos potenciales en la salud de manera crónica (JECFA 2006, García-Repetto y Repetto 2010). El Comité Mixto FAO/OMS de Expertos en Aditivos Alimentarios (Joint FAO/WHO Expert Committee on Food Additives-JECFA) de la Organización Conjunta de Alimentación y Agricultura y la Organización Mundial de la Salud (FAO/OMS) es uno de los tres comités del Codex que se encargan de aplicar el análisis de riesgos y confiar en el asesoramiento científico independiente proporcionado por organismos de expertos organizados por la FAO/OMS para el desarrollo de normas.
275 Inocu I dad al I mentar I a
El JECFA estableció principios para el uso de aditivos alimentarios, formuló recomendaciones sobre los métodos para establecer su seguridad en el uso y para la evaluación de los peligros cancerígenos. Actúa como un comité científico independiente que realiza evaluaciones de riesgo y brinda asesoramiento a la FAO, la OMS y los países miembros de ambas organizaciones. Si bien no forma parte oficial de la estructura de la Comisión del Codex Alimentarius, brinda asesoramiento científico independiente a la Comisión y sus comités de especialistas, como el Comité del Codex sobre Residuos de Medicamentos Veterinarios en los Alimentos (CCRVDF) para establecer límites máximos de residuos (LMR) para medicamentos veterinarios (Boison 2017).
2.1 Límites máximos de residuos (LMR)
En términos generales, las trazas que dejan los plaguicidas en los productos tratados, o las que dejan los medicamentos veterinarios en los animales, se denominan “residuos”.
residuos de plaguicidas: Un límite máximo de residuos (LMR) es el nivel máximo de residuos de un plaguicida que se permite legalmente en los alimentos o piensos (tanto en el interior como en la superficie) cuando los plaguicidas se aplican correctamente conforme a las buenas prácticas agrícolas (García Repetto y Repetto 2010). La definición más apropiada de residuo de plaguicida es la que se recoge en el Codex Alimentarius (FAO/OMS) que entiende por residuo de plaguicida a: “todas las sustancias presentes en un producto alimenticio destinado al hombre o a los animales como consecuencia de la utilización de un plaguicida”.
Residuos de medicamentos veterinarios: El límite máximo de residuos (LMR) es la concentración máxima de residuos legalmente permitida en un producto alimenticio obtenido de un animal al que se le ha administrado un medicamento veterinario (FAO/WHO 2019).Para los residuos de medicamentos veterinarios en los alimentos, los términos de referencia del JECFA se establecieron para:
• Elaborar principios para evaluar su seguridad y para cuantificar sus riesgos;
• Establecer una ingesta diaria aceptable (IDA) y otra orientación de valores para la exposición aguda;
• Recomendar límites máximos de residuos (LMR) para tejidos diana;
• Determinar los criterios apropiados para, y evaluar, los métodos de análisis para detectar y / o cuantificar los residuos en los alimentos. Los principales objetivos de este programa son proteger la salud del consumidor, garantizar prácticas comerciales justas en el comercio de alimentos y promover la coordinación de todo el trabajo sobre normas alimentarias realizado por organizaciones internacionales gubernamentales y no gubernamentales. En este mismo contexto, los LMR son considerados factores de seguridad para la inocuidad de alimentos cuyos procesos de producción im-
276 desarrollo sostenible
plican la utilización de plaguicidas o de origen animal con aplicación de medicamentos de uso veterinario. De ahí que, establecer los LMR de un sistema alimento-compuesto plaguicida o medicamento, se realiza previa “evaluación del riesgo”, considerando su toxicidad intrínseca (peligro) y la exposición mediante la alimentación (ingesta) y es una manera de establecer un control para el consumo seguro de alimentos fructo-hortícolas y/o de origen animal.
En el año 2005 se actualizaron los principios y métodos de evaluación de riesgos para LMR para plaguicidas y medicamentos veterinarios, organizada conjuntamente por FAO/RIVM/OMS, en Bilthoven, Países Bajos. El Comité Mixto FAO/OMS de Expertos en Alimentos y Aditivos en el 2006 decidió implementar el concepto de usar valores de residuos medios para estimar las ingestas diarias de residuos de medicamentos veterinarios en alimentos para las estimaciones de ingesta de exposición crónica (JECFA 2006).
Determinar estos factores de seguridad (LMR) constituye uno de los desafíos de los países no desarrollados para velar por la inocuidad y seguridad alimentaria, donde el Estado es un actor fundamental, considerando que dentro de todo sistema alimentario, este es responsable de normar, regular y direccionar la implementación de un sistema alimentario con base en las necesidades específicas y la cultura, para que éste sea sostenible en el tiempo y sensible a la nutrición, además de involucrarse en la regulación de la inocuidad de los alimentos estableciendo los LMR, el funcionamiento de los mercados y la elaboración de estándares de agricultura y alimentación (FAO 2017).
El Comité consideró los criterios actuales establecidos por el Codex para que los medicamentos veterinarios sean evaluados por el JECFA. Actualmente el Codex realiza un proceso de priorización de medicamentos veterinarios para la evaluación de los LMR y el JECFA realiza el proceso de evaluación de riesgos del medicamento veterinario, el problema es que en ocasiones hay datos limitados o no disponibles para la evaluación de compuestos para llegar a conclusiones sobre las IDA y los LMR. El Comité evalúa los datos disponibles, incluidos los presentados por el patrocinador y los identificados en una búsqueda de literatura abierta. Las decisiones del Comité dependen de la consideración de los datos primarios. Así, en estos casos, no se puede completar su evaluación debido a vacíos significativos en la base de datos (JECFA 2006).
Ciertos países lideran este proceso de establecer LMR como Estados Unidos, Japón y China y constituyen uno de los temas de interés actual en investigación, como lo demuestra el gráfico de tendencia de publicaciones científicas en SCOPUS (Fig. 2) utilizando como palabra clave los LMR (o MRL por sus siglas en inglés), alcanzando su máximo de 456 artículos en el 2018, duplicando lo reportado en el año 2000 con 204 artículos científicos.
277 Inocu I dad al I mentar I a
Número de documentos científicos sobre
Figura 2. Tendencia de publicaciones por año en SCOPUS sobre LMR.
Ahora bien, todos los países deben tener acceso a una evaluación de riesgo confiable de los productos químicos en los alimentos, pero no todos tienen la experiencia y los fondos disponibles para realizar evaluaciones de riesgo separadas en un gran número de medicamentos veterinarios y otros productos químicos. Algunos países utilizan la información del JECFA para establecer programas nacionales de control de inocuidad de los alimentos y el CCRVDF elabora normas basadas en las evaluaciones del JECFA. Según los términos del acuerdo sanitario y fitosanitario (MSF), las normas científicas basadas en el riesgo deben emplearse en el comercio internacional de alimentos. Por lo tanto, los gobiernos generalmente solicitan el asesoramiento de los comités del Codex y, en consecuencia, del JECFA y otros organismos científicos internacionales, sobre la implementación de las normas nacionales y la legislación relacionada con la inocuidad de los alimentos.
Por su parte, la FAO y la OMC proporcionan a los gobiernos los medios para establecer un marco que facilite el comercio sobre la base de normas alimentarias internacionalmente acordadas. Mediante la Comisión Mixta FAO/ OMS del Codex Alimentarius, los gobiernos elaboran normas alimentarias con una base científica (Boison, 2017). Gracias a la labor del Codex se proporcionan recursos valiosos a los gobiernos para lograr objetivos de salud pública, como la inocuidad de los alimentos y la nutrición, y se sientan las bases para los intercambios comerciales. El sistema de normas alimentarias y comerciales se sustenta en la labor sumamente técnica que tiene lugar en el Codex y la OMC, y que está dirigida por los miembros.
278 desarrollo sostenible 456 339 299 330 284 250 267 211 187 164 146 119 86 45 20 1 0 50 100 150 200 250 300 350 400 450 500 1950 1960 1970 1980 1990 2000 2010 2020
LMR Año
Para poder participar y cooperar a nivel internacional, los países deben invertir lo suficiente en la inocuidad y el control de los alimentos, y los gobiernos deben tener la capacidad nacional necesaria para coordinar de manera eficaz a todas las partes interesadas. Ambos aspectos tienen repercusiones en el marco del Codex y la OMC: por un lado, la posibilidad de participar en la formulación de las normas alimentarias y comerciales y, por otro, de beneficiarse de los instrumentos que proporciona este sistema para mejorar la inocuidad de los alimentos a escala nacional e incrementar las oportunidades de exportación (FAO y OMC 2018).
La IDA es un resultado de una evaluación de riesgos del compuesto, después de la aplicación de los dos primeros pasos del paradigma de evaluación de riesgos: identificación de peligros y caracterización de peligros (García-Repetto y Repetto 2010). Como tal, representa un valor de orientación basado en la salud, donde se considera que la exposición crónica representa un riesgo insignificante para los consumidores si no supera este valor. La IDA tiene varios usos en la evaluación de riesgos y la gestión de riesgos, sólo uno de los cuales sirve para obtener los LMR recomendados.
El LMR y la IDA son productos separados del proceso de evaluación de riesgos y tienen diferentes propósitos. La IDA se deriva del Nivel sin Efecto Adverso Observable NOEL o Nivel de efecto más bajo observado (Lowest observed adverse effect level LOAEL, por sus siglas en inglés) de los estudios toxicológicos apropiados, utilizando un factor de seguridad. Dado que existen suposiciones e incertidumbres en la obtención de la IDA, como el uso de factores de seguridad, el uso de una gama de dosis en estudios toxicológicos y la variación biológica normal, es más significativo expresar la IDA. El procedimiento de recomendación de LMR no se deriva directamente de la IDA. Si la IDA se basa en puntos finales toxicológicos, se consideran todos los residuos de relevancia toxicológica; si la IDA se basa en puntos finales microbiológicos, se consideran todos los residuos de relevancia microbiológica (JECFA 2006).
Por otra parte, los residuos de plaguicidas son claves para establecer la inocuidad de los alimentos. El concepto de residuo engloba no sólo a los restos de la molécula del plaguicida en su forma original sino a todos los productos de reacción o conversión, es decir, a todos sus metabolitos con significación toxicológica. También se engloban dentro de este concepto de residuo a todas las sustancias constituyentes de la formulación: material inerte, coadyuvantes, impurezas, así como sus metabolitos, ya que en ocasiones todas estas sustancias pueden presentar toxicidad propia.
Desde un punto de vista analítico se pueden diferenciar cuatro tipos de residuos:
• La sustancia activa y sus metabolitos primarios libres, por lo general de carácter lipófilo;
• Productos conjugados, de la sustancia original o de sus metabolitos, de naturaleza química variada y son normalmente hidrosolubles;
279 Inocu I dad al I mentar I a
• Metabolitos ligados covalentemente que son insolubles;
• Productos de descomposición de la sustancia activa, los cuales pueden ser muy variados dependiendo de factores ambientales, y la biodiversidad de microorganismos presentes.
2.2 Criterios para definir a los LMR
Dos son los criterios básicos que se establecen para determinar los LMRs: Criterio toxicológico y Criterio agronómico. Esto considerando que los límites deben asegurar que la ingestión diaria de los residuos no provocará efectos negativos sobre la salud y por otra parte el plaguicida o medicamento debe lograr una eficacia adecuada sobre la plaga/enfermedad a combatir con el menor número de aplicaciones posibles.
2.2.1 Criterio toxicológico
Este criterio considera que la ingestión diaria del plaguicida o medicamento, a lo largo de toda una vida (exposición crónica), no provoque efectos adversos sobre la salud de los consumidores (García-Repetto y Repetto 2010). Se establece la “Dosis sin efecto observable” (DSEO) del compuesto en estudio sobre animales de experimentación, que sería la mayor concentración o cantidad de una sustancia, hallada experimentalmente o por observación, que no causa alteraciones detectables en la morfología, capacidad funcional, crecimiento, desarrollo o duración de la vida de los organismos diana, bajo condiciones definidas de exposición.
Luego se extrapola la DSEO determinada en animales de experimentación, a la especie humana. Para ello, se aplican unos coeficientes de seguridad con el fin de obtener la ingesta diaria admisible (IDA); estimación de la cantidad total del compuesto contenida en los alimentos y/o agua de bebida, expresada respecto a la masa corporal, (mg/Kg), que puede ser ingerida diariamente durante toda la vida, sin riesgo apreciable para la salud.
La obtención de la IDA se realiza a partir de la dosis sin efecto observable (DSEO), generalmente el correspondiente a la especie más sensible sobre la que se ha determinado, por 100 que es la cifra que se toma como factor de seguridad mediante la siguiente fórmula:
NOAEL
IDA(mg/día)=
Factor seguridad
Donde:
NOAEL=DSEO = dosis sin efecto observable (mg/Kg peso corporal por día)
FS = Factor de seguridad (Medida es adimensional =10 cuando la DSEO es de la misma especie; =100 cuando es de otra especie; =mayor de 100 cuando la DSEO es en otra especie y la información disponible no es concluyente).
280 desarrollo sostenible
Posteriormente se calcula el nivel permisible de residuo para el hombre en un alimento determinado. Para calcularlo se multiplica el valor obtenido para la IDA por el peso promedio de un adulto sano (por ej. 60 Kg), y se divide por un “factor alimentario” que representa a la ingesta promedio per cápita del alimento, expresado en kilogramos. Esto indica la importancia de contar con datos de ingesta del alimento a través de: Encuestas alimentarias nacionales y Guías alimentarias de alimentación y nutrición.
Para establecer de manera más precisa la IDA del compuesto evaluado en función a cada tipo de alimento. El factor alimentario presupone el conocimiento de la dieta media, por ejemplo en varios países europeos se considera que el factor alimentario para productos hortofructícolas es de 0,4 Kg. De esto se desprende que el cálculo del nivel permisible de residuo de plaguicida en un producto vegetal desde un punto de vista toxicológico será:
Nivel permisible (mg/Kg)=
NOAEL*Peso
Factor seguridad x Factor alimentario
La Figura 3 presenta de manera general el esquema para el establecimiento de los LMR de plaguicidas y medicamentos de uso veterinario en animales para la alimentación.
2.2.2 Criterio agronómico
El procedimiento de recomendación de LMR también tiene en cuenta las condiciones de uso (por ejemplo, el uso del medicamento veterinario según las buenas prácticas en el uso de medicamentos veterinarios o GPVD) y los residuos que resultan de dicho uso (por ejemplo, estudios de eliminación de residuos). Una vez establecido el nivel permisible, es necesario realizar ensayos de campo con el fin de conocer el residuo real del plaguicida objeto de estudio que queda sobre los alimentos. Cuando los cultivos son tratados siguiendo las Buenas Prácticas Agrícolas (BPA) o el residuo que queda luego del metabolismo del animal que es tratado con el medicamento veterinario, siguiendo las Buenas Prácticas Veterinarias (BPV), estos estudios de campo incluyen el estudio de curvas de decaimiento de residuo e intervalo de confianza. También considera los resultados de los estudios de residuos radiomarcados, la biodisponibilidad de los residuos ligados, la identificación de tejidos diana y un residuo marcador, la disponibilidad de métodos analíticos prácticos, la exposición estimada resultante de los LMR recomendados y la consideración de la extensión de los LMR a tejidos, huevos y leche de otras especies (García-Repetto y Repetto 2010, JECFA 2006).
281 Inocu I dad al I mentar I a
ESTUDIOS TOXICOLÓGICOS
Distribución y metabolismo.

ESTUDIOS DE CAMPO
Buenas prácticas agrícolas
Buenas prácticas veterinarias

INGESTA DIARIA ADMISIBLE (IDA)

rESIDuO MArCADOr

Curvas de decaimiento de residuo e intervalos de confianza

Mediana de residuo


INGESTA ≤ IDA

LMr aceptado Opción de ajustar LMr
Evaluación de la Ingesta



rESIDuO TOTAL

LÍMITE MÁXIMO DE rESIDuO (LMr)

Figura 3. Esquema de establecimiento de LMR para plaguicidas y residuos de medicamentos veterinarios en animales de alimentación. Adaptado de Residue evaluation of certain veterinary drugs (JECFA 2006).
Las buenas prácticas agrícolas y veterinarias aseguran que las condiciones de empleo de un plaguicida o medicamento son las necesarias y suficientes para lograr el grado de protección deseado respecto a la plaga o enfermedad combatida. El objetivo final sería conseguir una alta eficacia y al mismo tiempo minimizar los riesgos toxicológicos y ambientales. Para ello, por ejemplo, en las BPA se aconseja:
• Utilizar aquellas alternativas más inocuas, menos contaminantes;
• Utilizar métodos de tratamientos con plaguicidas sólo cuando sea necesario para el cultivo;
• No sobrepasar las dosis recomendadas en el etiquetado;
• Respetar plazos de seguridad entre el tratamiento con plaguicida y la cosecha.
Los LMR se fijan teniendo en cuenta:
• Los residuos que quedan en las cosechas cuando se utilizan los plaguicidas siguiendo las buenas prácticas agrícolas y siempre que no se
282 desarrollo sostenible
LM
supere la IDA. Como los criterios de buenas prácticas agrícolas pueden ser diferentes entre los distintos países, los LMR también lo son (García-Repetto y Repetto 2010);
• Los residuos que quedan en el alimento animal siguiendo las buenas prácticas veterinarias y siempre que no se supere el IDA.
La consideración inicial al recomendar un LMR es si es lo suficientemente protector de la salud humana. Si el uso del medicamento veterinario produce una ingesta estimada de residuos de medicamentos veterinarios de acuerdo con la IDA, los LMR recomendados pueden ajustarse en consecuencia al tomar en cuenta los otros factores mencionados anteriormente. Como principio general, no recomendará un LMR que resulte en niveles de residuos que conduzcan a una ingesta alimentaria superior a la IDA basada en consideraciones toxicológicas o microbiológicas (FAO/WHO 2019).
Para proteger a los consumidores en todos los segmentos de la población, históricamente las recomendaciones de LMR estaban basadas en ingestas estimadas, utilizando una dieta de acuerdo a las guías alimentarias recomendadas. Anteriormente, se estimaba utilizando las ingestas para obtener una ingesta máxima diaria teórica (TMDI). Actualmente se utiliza los niveles medios de residuos para obtener una ingesta diaria estimada (EDI) para reflejar mejor las estimaciones de la exposición crónica (de por vida) (JECFA 2006).
Cuando los resultados de los estudios de distribución y metabolismo, las pruebas de campo y la evaluación de la ingesta del alimento estudiado, es decir, la evaluación del riesgo del consumo de un alimento con residuo de plaguicidas o medicamentos de uso veterinario, el JECFA, basado en la información científica disponible, normaliza que no existe un nivel seguro de residuos del compuesto o sus metabolitos en los alimentos, que represente un riesgo aceptable para los consumidores (Codex 2018).
En este contexto, un estudio realizado en Alemania utilizó datos de monitoreo de LMR de 700 plaguicidas en alimentos para evaluar el riesgo a la salud considerando simultáneamente el consumo diario completo en la dieta. Se concluyó que en el 99% de los casos, era poco probable que la exposición a la dieta presentara una preocupación crónica o aguda de salud pública para la población Alemana. En contraste, la exposición a la dieta a corto plazo a algunos plaguicidas específicos como el clorpirifos o la acumulación del dimetoato y el omethoate, podían presentar un problema de salud pública, lo que sugiere que las autoridades competentes deberían prevenir la presencia de estos residuos en los alimentos de producción local o regional estudiado caso por caso (Sieke et al. 2018).
Actualmente el Codex alimentarius ofrece una base de datos que contiene los LMR para los plaguicidas y los límites máximos para residuos extraños (LMRE) hasta su 39° período de sesiones, inclusive (julio de 2016). En la base de datos, los usuarios pueden obtener información acerca de los LMR y los LMRE tanto para un plaguicida como para varios y para un producto básico o
283 Inocu I dad al I mentar I a
un grupo de ellos. Los nombres y las definiciones de los productos básicos se pueden encontrar en la Clasificación de Alimentos y Piensos (Codex Alimentarius Commission Joint FAO/WHO Food Standards Programme 2019).
Los alimentos enumerados no deben contener una cantidad mayor de residuos de plaguicidas (definidos, individualmente, en la definición del residuo) que la que señala el LMR o LMRE (en mg/kg) en: a) el punto de entrada en un país; b) el punto de entrada en los canales comerciales de un país. Dicho límite máximo no se podrá exceder a partir de entonces. Los LMR y LMRE son de aplicación para el contenido en residuos de la muestra final representativa del lote y de la porción de los productos básicos analizados. Al buscar los LMR de un producto (por ejemplo: FC 0204 Lemon), se recomienda buscar también los LMRs de los correspondientes subgrupos (por ejemplo: FC 0002 Lemons and Limes) y grupos (por ejemplo: FC 0001 Citrus Fruits) para obtener toda la gama de los LMRs del para este producto en concreto.
2.3 Acreditación de laboratorios como garantía de calidad en los sistemas de control de los LMr
El análisis y aseguramiento de la calidad de los resultados analíticos son herramientas fundamentales para el apoyo a la seguridad alimentaria de las poblaciones. La necesidad de mejora de la calidad de las medidas obtenidas por los laboratorios, además de la propia exigencia como científicos para la obtención de resultados correctos, es demandada recientemente con insistencia por el mercado a laboratorios de ensayo en todos los campos, ya sean laboratorios de ensayos físicos, químicos, microbiológicos, etc. En los laboratorios de ensayos de control de calidad e inocuidad, esta necesidad se ve reforzada por la implicancia legal de los resultados de los ensayos obtenidos. Como el criterio decisión de apto o no apto para consumo está basado en un límite máximo permitido además de tener un valor veraz se fue incrementando la presión por disminuir la incertidumbre de las determinaciones a los efectos de contar con resultados confiables. Estos ensayos o análisis deben ser comparables y dar resultados semejantes independientemente del laboratorio que los realice. Por onde todo lleva a la acreditación de los laboratorios que hagan estos ensayos bajo la norma ISO/IEC 17025:2018.
CONSIDErACIONES FINALES
En conclusión, la presencia de riesgos para la inocuidad de los alimentos se debe a factores dentro y fuera de la cadena de suministro de alimentos, como el clima, la economía y el comportamiento humano. Las interacciones entre estos factores y la cadena de suministro son complejas y se necesita un sistema o un enfoque holístico para revelar las rela-
284 desarrollo sostenible
ciones de causa a efecto y poder realizar acciones de mitigación eficaces para minimizar los riesgos de inocuidad de los alimentos (Bouzembrak y Marvin 2019).
Aún son necesarios trabajos de investigación como estudios nacionales de ingesta diaria de alimentos y las caracterizaciones de sus residuos para sobre ello tener los IDA nacionales y poder tomar medidas eficaces para mitigar los riesgos actuales. Lo concreto es que al nivel actual de estos factores, los LMR y su monitoreo son claves como factores de seguridad en relación a los plaguicidas y/o residuos veterinarios y el riesgo de intoxicación crónica con estos compuestos a través de los alimentos.
REFERENCIAS BIBLIOGRÁFICAS
Boison JO (2017) The role of validated analytical methods in JECFA drug assessments and evaluation for recommending MRLs, Drug testing and analysis, 8(5-6):578-583.
Bouzembrak Y, Marvin HJP (2019) Impact of drivers of change , including climatic factors, on the occurrence of chemical food safety hazards in fruits and vegetables: A Bayesian Network approach, Food Control, 97:67–76. Codex (2018) Límites máximos de residuos (LMR) y recomendaciones sobre la gestión de riesgos (RGR) para residuos de medicamentos veterinarios en los alimentos. http://www.fao.org/fao-who-codexalimentarius/sh-proxy/ en/?lnk=1&url=https%253A%252F%252Fworkspace.fao.org%252Fsites%252Fcodex%252FStandards%252FCXM%2B2%252FMRL2s.pdf.Acceso Agosto 2019.
Codex Alimentarius Commission Joint FAO/WHO Food Standards Programme (2019) Residuos de plaguicidas en los alimentos y piensos. http://www.fao. org/fao-who-codexalimentarius/codex-texts/dbs/pestres/es/. Acceso Marzo 2019.
Dahdouh S et al. (2018) Global food composition database for phytate version 1.0 - PhyFoodComp1.0. http://www.fao.org/3/i8542en/I8542EN.pdf. Acceso Agosto 2019.
FAO/WHO (2019) Límites máximos de residuos (LMR). http://www.fao.org/ fao-who-codexalimentarius/codex-texts/maximum-residue-limits/es/.Acceso Agosto 2019.
FAO (2017) Reflexiones sobre el sistema alimentario y perspectivas para alcanzar su sostenibilidad en America Latina y el Caribe, 20p. http://www.fao. org/3/a-i7053s.pdf. Acceso Agosto 2019.
FAO (2019) Inocuidad alimentaria. http://www.fao.org/food-safety/es/. Acceso Agosto 2019.
FAO, FIDA, UNICEF, PMA y OMS (2018) El estado de la seguridad alimentaria y la nutrición en el mundo. Fomentando la resiliencia climática en aras de la seguridad alimentaria y la nutrición, FAO, Roma, 218p. http://www.fao. org/3/i9553es/i9553es.pdf. Acceso Agosto 2019.
285 Inocu I dad al I mentar I a
FAO y OMC (2018) Comercio y normas alimentarias. http://www.fao.org/publications/card/en/c/I7407ES. Acceso Agosto 2019.
García-Repetto M, Repetto R (2010) Toxicología de los plaguicidas. In: Postgrado en Toxicología. CD-ROM Ilustre Colegio Oficial de Químicos, Sevilla, pp. 1–135.
INCAP (2011) Seguridad Alimentaria y Nutricional, conceptos básicos. INCAP. http://www.incap.org.gt/sisvan/index.php/es/acerca-de-san/conceptos/ marco-referencial-de-la-san. Acceso Agosto 2019.
JECFA (2006) Residue evaluation of certain veterinary drugs. http://www.fao. org/3/a0652e/a0652e00.htm. Acceso Agosto 2019.
PNUD (2019) Objetivos del Desarrollo Sostenible. Objetivo 2: Hambre cero. http://www.uy.undp.org/content/uruguay/es/home/sustainable-development-goals/goal-2-zero-hunger.html. Acceso Agosto 2019.
Rapallo R (2018) Retos para la realización del derecho a la alimentación, In: Taller Nacional sobre Políticas públicas y derecho a la alimentación y Nutrición. FAO, 24p. https://www.parlamericas.org/uploads/documents/Ricardo%20Rapallo%20-%20Presentation%20-%20SPA.pdf. Acceso Agosto 2019. Robinson RK, Batt CA, Patel PD (2019) The future of Food Safety. In: Babayev F, First FAO/WHO/AU, International Food Safety Conference, pp.12–13. Sieke C, Michalski B, Kuhl T (2018) Probabilistic dietary risk assessment of pesticide residues in foods for the German population based on food monitoring data from 2009 to 2014. Journal of Exposure Science and Environmental Epidemiology, 28(1):46–54.
WHO (2019) El futuro de la inocuidad de los alimentos. https://www.who.int/ es/food-safety/international-food-safety-conference. Acceso Marzo 2019.
286 desarrollo sostenible
PÉRDIDAS EN LA CADENA DE PRODUCCIÓN y COMERCIALIZACIÓN DE ALIMENTOS
Rosana Rotondo1 , Mauricio Ortiz Mackinson1 , David Balaban1 , Rodolfo Grasso1 , María C. Mondino1-2, Paula Calani1, Eduardo Vita Larrieu1-3 , Gabriela Montian1
1 Universidad Nacional de Rosario (UNR), Cátedra de Cultivos Intensivos, Facultad de Ciencias Agrarias, Campo Experimental Villarino, CC Nº 14, S2125ZAA, Santa Fe, Argentina. E-mail: rrotondo@unr.edu.ar
2 Agencia de Extensión Rural, Instituto Nacional de Tecnología Agropecuaria (AER INTA) Arroyo Seco, San Martín 528, Santa Fe, Argentina. E-mail: mondino.maria@inta.gob.ar
3 Agencia de Extensión Rural, Instituto Nacional de Tecnología Agropecuaria (AER INTA) Pago los Arroyos, Santa Fe, Argentina. E-mail: vitalarrieu.eduardo@inta.gob.ar
INTRODUCCIÓN
El aumento de la población mundial y del poder adquisitivo de las crecientes poblaciones de clase media en los países en desarrollo con mercados emergentes, resultará en un aumento proyectado de la demanda de alimentos de 50 a 70% para mediados de siglo (Bond et al. 2013, Godfray et al. 2010, Parfitt et al. 2010). En contraste con este aumento de la demanda mundial, se estima que casi mil millones de personas sufren desnutrición crónica y deficiencias nutricionales (Bond et al. 2013, UNEP 2014). Además, la seguridad alimentaria futura, que es la capacidad del mundo para proporcionar suficientes alimentos seguros y nutritivos para toda su población, está profundamente amenazada por las nuevas restricciones ambientales, como el cambio climático, la degradación de la tierra y la escasez de agua (Liu 2014, Wheeler y von Braun 2013). La cadena agroalimentaria es un sistema que agrupa actores económicos y sociales interrelacionados que participan articuladamente en actividades que agregan valor a un bien o servicio, desde su producción hasta los consumidores. Este sistema incluye a los proveedores de insumos y servicios, la transformación, industrialización, transporte, logística y otros servicios de apoyo como el de financiamiento y las políticas de gobierno (García Winder et al. 2009). La complejidad de una cadena agroalimentaria depende de diversos aspectos, tales como el nivel de desarrollo del país, la localización geográfica, tipo de producto, época del año, clima y la demanda del mercado, entre otros.
Stadnik MJ, Velho AC, Zorrilla SE (eds.) Desarrollo Sostenible en la Producción Agroalimentaria
287
17
1. PÉRDIDAS DE ALIMENTOS A NIVEL MUNDIAL
Las pérdidas de alimentos en una cadena agroalimentaria, en la mayoría de los casos, con excepción de eventos climáticos o catástrofes, están directamente relacionadas a acciones realizadas por uno o más participantes de la misma. Estas decisiones tomadas o los problemas que ocurren en un eslabón, pueden afectar la disponibilidad de alimentos, valor nutricional, calidad, inocuidad y costos en un eslabón posterior de dicha cadena (Fig. 1).

Figura 1. Cadena agroalimentaria en frutihortícolas (Ferratto et al. 2010).
Las pérdidas se refieren a la disminución de la masa de alimentos disponibles para el consumo humano, que tienen lugar en las etapas de producción, poscosecha y procesamiento de la cadena de suministro. Las pérdidas que ocurren al final de la cadena alimentaria (venta minorista y consumo final) se conocen como desperdicio, más relacionado con el comportamiento de los vendedores minoristas y los consumidores (Parfitt et al. 2010).
Si bien la pérdida y el desperdicio de alimentos existe en todas las regiones en diferentes niveles, en los países de ingresos bajos pertenecientes a las regiones de África subsahariana, África del Norte, Asia meridional y sudoriental y América Latina, los alimentos se pierden principalmente durante las primeras etapas de la cadena, debido a deficiencias durante su producción. Por el contrario, en países de regiones industrializadas de América del Norte,
288 desarrollo sostenible
Europa y Asia industrializada, el mayor desperdicio se encuentra en las etapas de distribución y consumo (Fig. 2) (INTA-RIA 2013).

Figura 2. Porcentaje de la producción total de alimento que se pierde y se desperdicia (Fuente: INTA-RIA 2013).
Las pérdidas y desperdicios de alimentos (PDA) producen aproximadamente 3.300 millones de toneladas métricas de dióxido de carbono equivalente que, si fueran un país, estaría en tercer lugar sólo por detrás de China y Estados Unidos (Lipinski et al. 2013) (Fig. 3).
A su vez, si se dimensionara la superficie empleada para producir los alimentos que no se aprovechan, ésta representaría 198 millones de ha por año (aproximadamente el tamaño de México ó 6,4 veces la provincia de Buenos Aires). Finalmente, para producir los alimentos que se desperdician, se emplean 173 millones de m3 de agua por año, que representan el 24% de toda el agua utilizada en la agricultura.
289 Pérdidas de alimentos

Figura 3. Comparación de toneladas métricas de dióxido de carbono producidas por países industrializados y por pérdidas y desperdicios de alimentos (PDA).
2. PÉRDIDAS DE ALIMENTOS EN LATINOAMÉRICA y ARGENTINA.
2.1 Cadena Hortifrutícola
La FAO estima que el 6% de las pérdidas mundiales de alimentos ocurren en América Latina y el Caribe. Las pérdidas y desperdicios de alimentos en América Latina por segmento de la cadena alimentaria pueden observarse en la Figura 4.
Consumo Manejo y almacenamento Mercado y distribuición
Procesamiento Producción
Producción
Procesamiento
Mercado y distribuición

Consumo
Manejo y almacenamento
Figura 4. Pérdidas de alimentos en América Latina por segmento de cadena alimentaria (FAO 2014).
En el caso de las hortalizas y frutas, la problemática es aún mayor que en el resto de los alimentos, dado que son productos altamente perecederos.
290 desarrollo sostenible
28% 22% 17% 6% 27%
Durante los procesos de cosecha, acondicionamiento, distribución y comercialización de hortalizas se producen pérdidas cuantitativas (cuando el producto no llega al consumidor), nutricionales y/o pérdidas cualitativas o daños (pérdidas de calidad comercial). En trabajos publicados por Kader (2007) se muestran valores de pérdida promedio para frutas y hortalizas que oscilan entre 5 y 25% en países desarrollados y entre 20 y 50% en países en desarrollo. En éstos últimos existe una gran deficiencia en la infraestructura del mercadeo, en la cual las pérdidas significativas de alimentos representan un considerable daño económico para los comerciantes, productores y consumidores. En Argentina existen 17 cadenas agroindustriales, importantes desde el punto de vista socioeconómico, que representan el 36% del empleo total. El 77,6% de esa cifra está representado por siete cadenas, correspondiéndole a las hortalizas y frutas el primer lugar con 20,1% (Llach et al. 2004). La provincia de Santa Fe participa con un 8% de la superficie frutihortícola nacional, que significa el 10% del producto bruta agrícola provincial (PBA).
2.2 Causas de pérdidas de hortalizas y frutas
La vitalidad de los productos frutihortícolas, sus características nutritivas y organolépticas contribuyen a la preferencia de su consumo en fresco. Son ingeridos, en muchos casos, sin previa cocción, por tal razón son necesarios múltiples cuidados para que lleguen a la mesa del consumidor con los atributos sensoriales (sabor, aroma, color y textura) por los que han sido adquiridos. El hecho de que estos productos sean órganos vivientes requiere la máxima atención para su correcto manejo.
Las condiciones de higiene a nivel de la recolección, empaque, transporte y comercialización, deben estar ajustadas para mantener niveles de contaminantes bióticos (microorganismos e insectos) y abióticos (plaguicidas, metales pesados y otros), dentro de límites tolerables, inocuos para la salud humana y la seguridad ambiental. El consumidor final recibirá un producto de buena calidad, si cada operación independiente en la cadena de manejo, minimiza el daño y la pérdida causados por condiciones inadecuadas de temperatura, pérdida de humedad, etileno y excesivo tiempo de almacenamiento.
La tasa de deterioro varía ampliamente entre productos dependiendo de su metabolismo y en algunos casos, puede ser muy rápida. Los procesos fisiológicos más importantes durante la poscosecha son la respiración y la transpiración. La velocidad a que respira un producto constituye un índice de la actividad metabólica de sus tejidos y es una guía útil para calcular la duración de su vida comercial (Wills et al. 1999). Algunos órganos se tornan amarillentos (degradación de la clorofila) y otros sufren cambios composicionales (azúcares, sustancias nitrogenadas, etc.), haciendo que los productos pierdan valor comercial y aumente su descarte.
La disminución de las pérdidas depende en gran parte de la capacidad y efectividad del sistema de comercialización, o de prácticas que se utilicen
291 Pérdidas de alimentos
para reducir la velocidad de estos procesos. El almacenamiento refrigerado se recomienda para muchos productos perecederos ya que retarda el envejecimiento causado por maduración, ablandamiento o cambios de textura, cambios metabólicos indeseables, producción de calor por respiración y la pérdida de humedad con el consiguiente marchitamiento (Handenburg et al. 1988).
La transpiración es otra de las causas del deterioro ya que el principal componente de estos productos es el agua (80-95% de su peso) y la pérdida de la misma no sólo trae como consecuencia una disminución del peso, sino también la formación de un producto flácido, poco atractivo y con disminución notable de la calidad comercial (Nunes et al. 2009).
La intensidad de la transpiración puede reducirse aumentando la humedad relativa, disminuyendo la temperatura del aire y usando envolturas protectoras. La humedad relativa óptima, para disminuir la pérdida de agua por transpiración de la mayoría de los productos hortícolas para diferentes temperaturas es del 100% (Handenburg et al. 1988). La inmersión de los productos en agua durante un período determinado antes de ser colocados en góndola es una técnica aconsejada para mantener la turgencia de los mismos. Los problemas de deshidratación son mínimos en órganos de reserva, como en las hortalizas de raíz y tubérculos y máximos en las hortalizas foliáceas o con parte de tejidos en activo crecimiento (Namesny 1993).
La cadena de distribución generalmente carece de instalaciones ideales para almacenar cada producto en condiciones adecuadas y requiere que todos los integrantes contemplen la necesidad de mejorar el manipuleo, la temperatura y la humedad relativa para limitar las pérdidas de calidad. Esta situación puede llevar al estrés fisiológico, pérdida de calidad y menor vida útil (Paull 1999).
3. CADENA DE COMERCIALIZACIÓN DE HORTALIZAS EN ROSARIO
3.1 Estrategias de buenas prácticas para un manejo sustentable
Argentina dispone de escasa información con respecto a esta problemática, y según Viteri et al. (2000) hasta el año 2000 no se había evaluado la incidencia de los daños producidos en el campo y durante el manipuleo sobre la calidad de las hortalizas.
En el cinturón hortícola de Rosario (Santa Fe, Argentina), se cultivan 5493 ha de hortalizas por año (Grasso et al. 2013), siendo el más importante de la provincia, no sólo por su producción, sino también por la actividad comercial que se realiza principalmente a través de dos mercados concentradores que abastecen a más de 1,5 millones de habitantes. Actualmente se evidencia una crisis producida en la cadena de comercialización atribuible, entre otros motivos, a las elevadas pérdidas desde el productor al consumidor.
Muchos de los procesos posteriores a la cosecha pueden ser generadores de pérdidas. Se pueden mencionar las deficiencias en los transportes del
292 desarrollo
sostenible
productor y minorista (falta de protección, ausencia de frío), envases inadecuados (en cuanto a material y forma de envasado) y deficiencias en el traspaso de la mercadería de su envase original a otro para su exposición y conservación en cámara, sin el cuidado correspondiente. Las pérdidas se pueden manifestar e incrementar en la comercialización, dado que se trata de productos altamente perecederos y sensibles, que manifiestan mayores daños a medida que pasa el tiempo (Mondino et al. 2007).
Según Ferratto et al. (2010), el 90% del abastecimiento al consumidor se realiza a través de fruterías y verdulerías mientras que en el resto del país aproximadamente un 70% y el 30% por la gran distribución (supermercados).
En la ciudad de Rosario existen aproximadamente 2000 locales de venta minorista, que generalmente, se abastecen en los mercados mayoristas. Estos comercios se caracterizan por el escaso conocimiento sobre el manejo poscosecha; normalmente son empresas familiares, que se inician con escaso capital y luego, el ingreso les permite cubrir sólo los costos básicos sin posibilidad de reinvertir. No se aplican técnicas para mantener la calidad del producto, tales como la hidratación (inmersión en agua clorinada), utilización de envases especiales y conservación en cámaras frigoríficas. La mercadería se expone en el exterior de los locales, en los mismos cajones en la que fue comprada, teniendo alta incidencia a los factores climáticos y riesgos de contaminación que la desmejoran. Los productores cuentan con medios de transporte muy precarios, en muchos casos sin protección, lo cual se ve agravado por el horario en que la mercadería es transportada, generalmente al mediodía.
El equipo de docentes de la Cátedra de Sistemas Cultivos Intensivos, del Área Horticultura de la Facultad de Ciencias Agrarias de la UNR, estudió para el cinturón hortícola de Rosario, los diferentes canales de comercialización, y las causas de las pérdidas poscosecha y su magnitud en diversas hortalizas, y evaluaron propuestas de mejora para aumentar la eficiencia y sustentabilidad del sector.
3.2 Pérdidas de lechuga desde la cosecha al consumidor
En Rosario se cultivan 382 ha de lechuga, ocupando el segundo lugar luego de papa, con un volumen de producción de 98.000 t anuales (Grasso et al. 2013). Se evaluaron las pérdidas poscosecha e identificaron los factores (causas y condiciones), durante la cosecha, acondicionamiento y comercialización de lechuga producida y comercializada en el cinturón hortícola de Rosario, en tres épocas del año.
Las pérdidas poscosecha que se cuantificaron fueron elevadas, de los cuales un 21,2% se produjo entre la cosecha y la llegada al minorista y del 19,0% desde la llegada al minorista hasta las 24 h posteriores, totalizando un 40,2%. El inadecuado transporte de la lechuga en cajones de madera abrasivos en que ésta sobrepasa los envases, o los cajones atados con hilos, se traducen en importantes pérdidas de calidad de las mismas (Mondino et al. 2007).
293 Pérdidas de alimentos
3.3 Pérdidas en la comercialización de alcaucil
En Argentina, el alcaucil es cultivado principalmente en las zonas de La Plata, San Juan y Rosario. A lo largo de la cadena de comercialización sufre importantes pérdidas cuantitativas y cualitativas. Se observaron que los principales factores que contribuyen a las pérdidas poscosecha son los contenedores de mimbre (corva) utilizados en la cosecha que pueden resultar abrasivos, así como la falta de cobertura del alcaucil una vez cosechado y el tiempo de espera en el campo hasta su transporte. Sumadas a éstas pérdidas, en la etapa de venta tanto en mayoristas como en minoristas se observó la ausencia de refrigeración y acondicionamiento del producto.
En la Figura 5A, se observan los daños y pérdidas de calidad de los capítulos de alcaucil al llegar a las verdulerías (Firpo et al. 2007). Se consideró un período de evaluación de 4 días y en capítulos cortados longitudinalmente se observaron los siguientes resultados: el diámetro ecuatorial de los capítulos disminuyó con el paso de los días, mientras que el % de pérdida de peso, pardeamiento y de brácteas abiertas externas, se incrementaron (Firpo et al. 2007), resultados expresados en la Figura 5B.




Figura 5. A) Porcentaje de daños y pérdidas (%) en capítulos de alcaucil al llegar al comercio minorista y B) porcentaje de pérdida de peso, pardeamiento y brácteas externas abiertas al día 2 y 4 de almacenamiento.
Se evidenció mayor porcentaje de coloración violácea en brácteas internas durante el período evaluado, en cambio en el pardeamiento de brácteas internas y longitud del pappus no se observaron diferencias (Firpo et al. 2007).
3.4 Evaluación de sistemas y procesos en tomate
En el cinturón de Rosario, el tomate, según el valor económico de su producción ocupa el tercer lugar luego de papa y lechuga (Ferratto et al. 2009).
Las mayores pérdidas ocurren en la cosecha y en el embalado, donde los frutos se aprietan excesivamente y en muchos casos sobresalen del cajón (Castro
294 desarrollo sostenible
71 24 4 1 0 10 20 30 40 50 60 70 80 Heridas roces Enfermedades Plagas Pérdidas (%) Tipos de daños 37 17 8 57 20 22 0 10 20 30 40 50 60 70 80 Brácteas externas abiertas Pardeamiento Pérdida de peso Pérdidas (%) Tipos de daños 2 días 4 días B A
2001, Vilela y Luengo 2002, Nakama y Lozano Fernández 2008). A su vez el transporte de la mercadería es inadecuado, ya que se realiza sin protección y sin refrigeración. Aldaz y Romero (1986), determinaron que las mayores pérdidas se producen a nivel de minoristas, debido al manejo inadecuado en todas las etapas anteriores.
Se evaluaron dos sistemas de producción, bajo invernadero y a campo y se registraron diferencias en marcas sobre los frutos (depresiones y rotura de tejidos producidas por una compresión con los bordes del cajón o uñas del operario) y magulladuras (ablandamiento y cambio de color de los tejidos, causado por impacto del fruto, compresión del mismo dentro del cajón y la presión de los dedos del operario). Los valores de daños (marcas y magulladuras) producidos bajo invernadero fueron menores ya que recibieron un manipuleo más adecuado, pero presentaron mayor pérdida de peso a la semana de almacenamiento sin refrigeración. La magnitud de las pérdidas y daños no presentaron diferencias entre las etapas de cosecha, empaque y transporte a mercado, con lo cual consideramos que los daños principales se producen durante la cosecha.
Como alternativa a la cosecha tradicional (los frutos son volcados a cajones de madera que presentan bordes desparejos, clavos, tablas rotas (Fig. 6A). Se realizó un ensayo con cajones cosecheros de plástico forrados con espuma de polietileno de 5 mm de espesor (Fig. 6B) y con dos estados de madurez: “pinto” (cuando el fruto tenía una coloración roja de hasta el 20%) y “color” (cuando la coloración roja era entre un 80 a 100%). En las condiciones evaluadas, la nueva práctica de cosecha permite reducir a menos de la mitad la cantidad de daños en todas las fechas. Los daños y pérdidas son mayores a medida que pasa el tiempo, explicado por el aumento de la visualización de magulladuras (Fig. 6C) y por la pérdida de agua.

Figura 6. A) Envases de madera para la cosecha convencional. B) Cajones forrados con espuma de polietileno para la nueva práctica de cosecha. C) Marcas (fruto de la izquierda) y magulladuras (frutos de la derecha), al día siete de almacenamiento. UNR, Zavalla, Santa Fe.
295 Pérdidas de alimentos
Para la cosecha convencional el cajón cosechero tiene incidencia en el número de marcas, siendo más afectados los frutos ubicados en los bordes para el estrato superior y medio, en el estado “color”. Las magulladuras se producen en las etapas de cosecha y no están en función a la ubicación dentro del envase de madera (Ferratto et al. 2010).
En nuestro país, la clasificación de frutos para su posterior comercialización se realiza en forma manual pero también existen establecimientos que procesan tomates a través de una línea de empaque mecanizada (Nakama y Lozano Fernández 2008). En los ensayos efectuados, se propone mejorar la clasificación manual mediante una plataforma inclinada, estructura para ubicar los cajones de modo que el operario pudiera depositar cuidadosamente los frutos en cada uno de ellos (Fig. 7A). La clasificación manual convencional presentó los mayores daños en los frutos con estado de madurez “pinto”, seguido por la plataforma inclinada y por último la mecanizada. En frutos “color”, los daños fueron menores en la clasificación con plataforma, seguido de la máquina y el método convencional. Al comparar las técnicas de clasificación sin tener en cuenta el estado de madurez, la convencional, presentó mayores daños en frutos durante una semana de estantería posterior a la cosecha, mientras que los clasificados con máquina manifestaron la mayor pérdida de peso durante todo el almacenamiento respecto a la tecnología propuesta (Rotondo et al. 2010).
A su vez se hicieron ensayos respecto al embalado de los frutos, el tradicional (acomodados en hileras con su eje ecuatorial vertical y en 3 estratos (Fig. 7B) y a granel (Fig. 7C), en ambos estados de madurez. Los frutos del estrato inferior presentaron mayor número de marcas y magulladuras, seguidos por los frutos de los bordes. También presentaron mayor pérdida de peso los frutos “color” con embalado tradicional respecto a los “pinto” (Firpo et al. 2010).

Figura 7. A) Tarima inclinada de clasificación de frutos de tomate. B) Embalado tradicional. C) Embalado a granel en estado de madurez color y pinto. UNR, Zavalla, Santa Fe.
296 desarrollo sostenible
Firpo et al. (2010) determinaron que los frutos “color” embalados en forma tradicional presentaron la mayor pérdida de peso y número de marcas durante el almacenamiento; mientras que los “pinto”, menor valor en ambas formas de embalado, sin diferencias entre ellas. Con respecto a magulladuras el embalado tradicional presentó mayor número que a granel, para ambos grados de madurez, al séptimo día. El daño interno por impacto en el fruto no se detecta durante el embalado, sino que al llegar al consumidor.
4. EFECTO DE TEMPERATURA y HIDRATACIÓN EN LAS PÉRDIDAS POSCOSECHA
Buscando disminuir las pérdidas poscosecha durante el almacenamiento minorista, se evaluó el efecto de la temperatura (sin cámara frigorífica: 13°C, 81% HR y con cámara: 3,4°C, 97% HR) y de la hidratación o revitalización (sin y con inmersión en agua clorinada 50 ppm, durante 5 minutos) en lechuga mantecosa, de hoja crespa, arrepollada, apio, zapallito y zanahoria. Las variables medidas fueron:
• Pérdida de peso por descarte (en % respecto al peso del día anterior); para hortalizas de hoja, se eliminaron hojas rotas, amarillas, deshidratadas, enfermas y base de tallo oxidado. Para zapallito se eliminaron los dañados, enfermos y sobremaduros. Para zanahoria, dañadas, enfermas, rajadas, brotadas, con amarronamiento y se realizó eliminación de ambos extremos;
• Pérdida o ganancia de peso por agua (en %, respecto al peso del día anterior); el resultado puede ser positivo o negativo, en función a la evaporación, transpiración y agua libre presente en la superficie de las hortalizas, aplicada por el mojado luego de la cosecha o por la hidratación durante el almacenamiento.
Según Firpo et al (2012), para las pérdidas por descarte, el ambiente con cámara frigorífica y la hidratación disminuyeron significativamente las pérdidas en todas las especies (Fig. 8A), excepto para zanahoria y lechuga arrepollada (presencia de nervadura rosada y pudriciones acuosas, principalmente en el ambiente sin cámara). En la mayoría de las especies el efecto de la interacción de los ambientes, hidratación y el tiempo fue significativo, es decir que el efecto del ambiente y la hidratación depende del tiempo de almacenaje. Para la variable pérdida o ganancia de peso por agua en cámara frigorífica, generalmente fue significativamente menor con respecto a sin cámara, con un comportamiento diferente entre especies (Fig. 8B).
Desglosando las interacciones de los modelos se encontró que en la mayoría de las especies la hidratación disminuyó la pérdida de agua en ambos ambientes a diferencia de lechuga crespa que ocurrió sólo sin la utilización de cámara. Generalmente la pérdida de agua fue más acentuada durante el primer período de almacenamiento, durante el cual el producto se va enfriando.
297 Pérdidas de alimentos




Figura 8. A) Pérdida de peso por descarte y por agua con y sin cámara frigorífica y B) Pérdida de peso con y sin hidratación. Promedio de todas las especies y días.
5. EFECTO DEL ALMACENAMIENTO, HIDRATACIÓN y MATERIAL DE SUjECIÓN, EN LAS PÉRDIDAS DE HORTALIZAS DE HOjAS, A NIVEL MINORISTA
Continuando con el trabajo anterior se incorporaron distintas formas de sujeción de los manojos (atado con cinta de papel adhesiva de 2 cm de ancho y atado con pasto fuerte o Stipa sp.), en época otoñal y estival. Las especies fueron acelga, rúcula, cebolla de verdeo, puerro y radicheta. El almacenamiento para otoño fue sin cámara frigorífica: 13°C; 81% HR y con cámara: 3,4°C; 97% HR. La hidratación se realizó como en el trabajo anterior. En otoño se observó que la pérdida por descarte en cámara frigorífica fue de 19,8% promediando todas las especies, los días de almacenamiento y la hidratación, en comparación con el ambiente no refrigerado, que fueron del 69,7% (Rotondo et al. 2013). En general, la hidratación redujo significativamente dicha pérdida, salvo en cebolla de verdeo donde el proceso de inmersión en agua la aumentó principalmente por podredumbres. La aplicación de frío e hidratación en rúcula no sólo disminuyó la pérdida, sino que permitió prolongar la vida útil hasta el séptimo día de almacenamiento, mientras que, en ambiente no refrigerado, al tercer día se descartó totalmente. La sujeción con cinta mostró diferencias estadísticas en radicheta y puerro, reduciendo el descarte (Fig. 9). Las interacciones entre ambientes e hidratación, tuvieron comportamiento diferente según la especie (Rotondo et al. 2013) . El almacenamiento en cámara frigorífica, en general, redujo significativamente la pérdida o ganancia de peso por agua (%), en promedio de todas las especies. La hidratación, en ambos ambientes, disminuyó la pérdida de agua, más aún, en esta experiencia resultó en una ganancia de peso de 6,2% (pro-
298 desarrollo sostenible 3 5 19 66 0 10 20 30 40 50 60 70 80 Por descarte Por água Pérdidas (%) Sin cámara Con cámara 43 9 43 -1 -10 0 10 20 30 40 50 60 70 80 Por descarte Por água Pérdidas (%) Sin hidratación Con hidratación B A
medio de todos las especies y días para hidratado y no hidratado), ya que al sumergirse el producto generó un aumento de agua en superficie y/o en los tejidos. El material de sujeción de los manojos no mostró efecto sobre la disminución del peso de esta variable (Rotondo et al. 2013).

9. Manojo de radicheta sujeto con cinta de papel (A) y con Stipa sp. (B)
En la época estival el almacenamiento sin cámara fue a 19,5°C, 87,4% HR y a 3,4 °C, 97% HR con cámara. La pérdida por descarte en los ambientes de almacenamiento y la técnica de hidratación a través del tiempo, varió diferencialmente en cada especie. La conservación refrigerada, con o sin hidratación, disminuyó las pérdidas poscosecha. Esto se debió a la reducción del descarte en todas las especies evaluadas, a la vez que se incrementó el período de almacenamiento destacándose en espinaca, radicheta y rúcula. La sujeción de los manojos con cinta no presentó diferencias estadísticas en ninguna especie, con respecto a Stipa sp. Para la pérdida de peso por agua, al igual que en trabajos anteriores, el almacenamiento en cámara redujo significativamente la misma. La hidratación, en ambos ambientes, no solo disminuyó la pérdida de peso, sino que resultó en un incremento en algunos tratamientos. El material de sujeción de los manojos no mostró efecto sobre la disminución del peso por pérdidas de agua en acelga, puerro y espinaca. En rúcula fue menor cuando se sujetó con cinta, en ambiente refrigerado. Se obtuvo el mismo resultado en radicheta y cebolla de verdeo, pero en ambiente no refrigerado (Ortiz Mackinson et al. 2014).
6. COMERCIALIZACIÓN MINORISTA DE HORTALIZAS EN ROSARIO
Con el objetivo de caracterizar la comercialización minorista de hortalizas, se evaluó la utilización de diferentes tecnologías y prácticas, para tres zonas de la ciudad de Rosario diferenciadas desde el punto de vista socioeconómico (porcentaje de hogares con privación de recursos corrientes). Se seleccionaron tres estratos sociales: bajo, medio y alto. En cada uno se estableció
299 Pérdidas de alimentos
Figura
un radio representativo de 50 a 70 manzanas, es decir áreas homogéneas en cuanto al estrato social y con un mínimo de verdulerías y fruterías.
Dentro del mismo se realizaron 20 encuestas a negocios minoristas tomados al azar. La mayoría de los encuestados expresó coincidencia en que las pérdidas poscosecha son importantes (83% de los consultados) y manifestaron valores similares en dos especies con un valor promedio de 30% para lechuga y 17% para tomate.
En la ciudad de Rosario, los negocios minoristas de los estratos sociales presentaron diferencias, aunque se observan características similares entre el bajo y medio y prácticas más adecuadas en el alto. Aún en los negocios ubicados en zonas de alto poder adquisitivo, no se observa un nivel de tecnología adecuada; las cámaras de frío son escasas, el acondicionamiento de la mercadería es insuficiente y escasa utilización de locales cerrados con aire acondicionado. La gestión es inadecuada, sin registros de información ni control de stock. Los negocios de los estratos bajo y medio presentaron algunas características comunes, en los aspectos relacionados al uso de frío, mesadas de lavado y una actitud diferente en cuanto al precio y calidad (Firpo et al. 2015).
6.1 Pérdidas poscosecha de hortalizas en la comercialización minorista El objetivo de este trabajo fue evaluar las pérdidas y daños producidos en hortalizas (lechugas mantecosas y de hoja crespa, apio, acelga, cebolla de verdeo, puerro, rúcula, tomate, pimiento y zanahoria), durante la distribución minorista en Rosario, con dos manejos, en época invernal y estival.
• Manejo tradicional de las hortalizas: la compra se realizó en los mercados concentradores; transportados sin protección, ni refrigeración; exhibición de los productos en góndola con el envase original, el local de venta y el almacenamiento sin refrigeración; no se realizó acondicionamiento de los productos, sólo se hizo alguna selección por la mañana o al momento de venta. Algunos productos estuvieron expuestos fuera del salón de venta.
• Manejo mejorado de las hortalizas: algunas hortalizas provenían directamente de un establecimiento de la zona, se cosecharon y transportaron de inmediato al local de venta en condiciones adecuadas. Otras se adquirieron en los mercados concentradores, se almacenaron en cámara, antes de ser colocados en góndola, se seleccionaron y algunas especies se hidrataron. Los productos durante el día se mantuvieron en el salón de venta refrigerado.
La pérdida de peso por descarte en el manejo mejorado, fue significativamente menor al tradicional, para ambos ciclos (estival e invernal) y en todas las especies (Fig. 10).
La manipulación y condiciones de almacenamiento en el manejo tradicional con alta temperatura y menor humedad relativa, generaron pérdidas elevadas especialmente en las especies de hoja como rúcula, acelga, lechuga
300 desarrollo sostenible
mantecosa y crespa. La zanahoria presentó los menores valores de pérdidas por sus diferencias anatómicas y fisiológicas. En todas las especies evaluadas y en ambas épocas, excepto puerro y verdeo, la pérdida de agua fue superior en el manejo tradicional que, en el mejorado, con valores más altos en las hortalizas de mayor área foliar (Ferratto et al. 2012). Según Grasso et al. (2014), para las pérdidas totales (descarte y agua), en el manejo tradicional fueron 45% mayores respecto al mejorado para el período estival y 23% para el invernal.


Figura 10. Pérdidas de agua, descarte y totales (%) para los manejos minoristas tradicional y mejorado en época estival e invernal.
6.2 Sistemas de producción y formas de sujeción en las pérdidas poscosecha
La composición y calidad de los productos hortícolas es influenciada por factores de precosecha, interrelacionados entre sí. Los mismos pueden ser el material genético, estado fisiológico del órgano cosechado, condiciones agroecológicas en las que se desarrolla el cultivo, fertilización, tecnología de producción, momento de cosecha, etc. Por lo tanto, la calidad comienza a determinarse mucho antes de la cosecha y es importante conocer cómo esos factores afectan el comportamiento de las hortalizas luego de la misma. Los sistemas que permiten un aumento de la calidad comercial y continuidad de la producción durante todo el año, presentando así un valor estratégico en el esquema de comercialización y vida poscosecha (Ferratto et al., 2010), han tenido una gran difusión entre los productores. Los sombreaderos son estructuras que sostienen malla media sombra para reducir la radiación, temperatura, evapotranspiración, aumentar la humedad relativa del ambiente y regular la humedad del suelo. Las mantas flotantes (agrotextiles), son plásticos, de fibras no tejidas, que constituyen un material muy liviano y de buena porosidad; se colocan directamente sobre las plantas para protegerlas de
301 Pérdidas de alimentos
12 3 9 4 53 17 33 14 65 20 42 19 0 10 20 30 40 50 60 70 80 90
estival Mejorado estival Tradicional invernal Mejorado invernal Pérdidas (%)
Tradicional
Tipo de manejo
Por agua
Por descarte Totales
sostenible
vientos y heladas. Los invernaderos son estructuras cubiertas de polietileno que permiten lograr un incremento del rendimiento comercial y calidad, acortamiento del ciclo productivo, continuidad de la producción y protección de heladas, lluvias, granizo, etc.
El objetivo del grupo de trabajo fue evaluar el efecto de los sistemas de producción y las formas de sujeción en las pérdidas poscosecha en los cultivos de rúcula, acelga y espinaca en distintas épocas del año producción. Se realizó en la Facultad de Ciencias Agrarias, UNR en un suelo Argiudol Típico, riego por goteo y el terreno sistematizado en platabandas de 1,4 m de ancho para el cultivo de acelga y en lomos a 0,70 m para los cultivos restantes.
En el caso de acelga se realizó trasplante, en 4 hileras, dos laterales de goteo y una densidad de 7,14 pl m-2 . En rúcula y espinaca, la siembra se realizó a chorrillo doble hilera sobre lomos, con una densidad de 15,6 y 14,4 kg ha-1 respectivamente. Se analizaron tres factores:
• Sistemas de producción [Invernadero de madera, a dos aguas, con polietileno LDT de 100 μm (I); Malla media sombra al 35% (MS); Manta flotante agrotextil (MF) y Campo (C)];
• Formas de sujeción [Manojo de hojas atado con cinta de papel adhesiva de 2 cm de ancho, de un peso aproximado de 250 g (A) y hojas a granel, con un peso equivalente al manojo (G)];
• Días de almacenamiento (cámara frigorífica a 3°C y 99% H.R). Se realizaron mediciones 3, 6 y 9 días posteriores a la cosecha). Las variables medidas fueron: pérdida por descarte y pérdida de peso por agua (%).
En las Tablas 1 y 2, se muestra un resumen de los resultados. Se observó que en las tres épocas de cultivo de rúcula, el invernadero fue el que presentó las menores pérdidas por descarte y por agua y en cuanto a la forma de sujeción, el atado con cinta de papel fue el que produjo menor pérdidas de peso por agua (Ortiz Mackinson et al. 2017).
En acelga, las diferencias entre sistemas de producción para la pérdida por descarte, sólo fueron en otoño, donde el invernadero y la manta flotante disminuyeron las mismas. Durante el almacenamiento, aumenta el descarte, en otoño e invierno. El atado con cinta de papel disminuye el descarte hacia el final del almacenamiento en primavera. Los sistemas invernadero y manta flotante disminuyen las pérdidas de agua en los días 3 y 6 de almacenamiento, en otoño y en primavera disminuyó hacia el final del mismo (Grasso et al. 2018). El comportamiento poscosecha para el ciclo otoñal e invernal de espinaca fue de menor pérdida de peso por agua en los tres sistemas de producción protegidos respecto al campo, en los primeros días de almacenamiento refrigerado. El descarte fue menor en los manojos de espinaca atados respecto a la presentación a granel durante los últimos días de almacenamiento, en otoño. En invierno se presentaron diferencias entre días de almacenamiento, siendo menor el descarte en los días iniciales de conservación refrigerada (Rotondo et al. 2018).
302 desarrollo
Tabla 1. Pérdida de peso por descarte (%) para sistemas de producción, formas de sujeción y días de almacenamiento, en los tres ciclos de cultivo de rúcula, acelga y espinaca.
Pérdida de peso por descarte (%)
Referencias: I-invernadero, MS-media sombra, MF-manta flotante, C-campo, A-atado, G-granel
Tabla 2. Pérdida de peso por agua (%) para sistemas de producción, formas de sujeción y días de almacenamiento, en los tres ciclos de cultivo de rúcula, acelga y espinaca.
Pérdida de peso por agua (%)
Referencias: I-invernadero, MS-media sombra, MF-manta flotante, C-campo, A-atado, G-granel
CONSIDErACIONES FINALES
Sabemos que es fundamental la producción de alimentos de manera sustentable y adecuada para todos los consumidores del mundo. Comprobamos que son muy elevadas las pérdidas de alimentos, especialmente en los países en desarrollo, superando el 50 % en el caso de frutas y hortalizas. Por
303 Pérdidas de alimentos
rúcula Acelga Espinaca Otoño Invierno Primavera Otoño Invierno Primavera Otoño Invierno Primavera
I A 15,6 11,5 97,5 2,9 12,9 0,0 7,1 9,5I G 0 8,8 95,9 0,0 20,5 9,9 10,2 12,7MS A 44,9 27,5 100 12,4 8,5 4,3 7,2 9,4MS G 38,5 30,0 100 0,0 13,2 3,5 11,1 11,3MF A 60,4 61,1 100 16,2 14,9 8,4 6,0 12,5MF G 61,1 51,2 100 10,6 14,5 17 8,3 13.4C A 49,7 28,9 100 28,9 28,1 4,6 8,8 9,8C G 57,2 28,7 100 17,7 30,5 16,7 11,4 12,9 -
rúcula Acelga Espinaca Otoño Invierno Primavera Otoño Invierno Primavera Otoño Invierno Primavera
I A 0,7 2,5 14,8 2,8 2,0 3,3 0,3 6,9
I G 1,4 3,6 19,9 2,5 3,7 4,3 7,9 8,9MS A 0,5 2,6 15,0 3,8 3,7 3,5 4,3 15,2MS G 1,1 2,5 19,7 4,9 2,5 3,9 9,4 14,8
MF A 7,2 5,7 16,5 3,4 1,7 5,5 3,2 10,3MF G 3,7 3,4 22,6 3,8 1,4 4,7 12 14,1C A 1,7 1,8 19,2 4,7 2,6 3,5 5,1 14,4
C G 6,7 1,6 25,3 4,6 2,7 7,0 6,9 13,3
-
-
-
lo tanto, hay que continuar estudiando estrategias de manejo que minimicen dichas pérdidas a lo largo de toda la cadena de producción y comercialización hasta llegar al consumidor.
Es necesario tomar conciencia del costo ambiental, económico y social que significa desperdiciar más de la mitad de lo que se produce. En muchos casos podría disminuirse el problema sin grandes inversiones, sino simplemente manejando más racionalmente los recursos, trabajando en equipo, planificando la producción, etc. Nuestra preocupación por este tema nos llevó a evaluar algunos aspectos de los procesos involucrados, ponerle valor a la realidad que conocemos y hacer un aporte al sector local de producción de hortalizas, buscando optimizar el sistema.
Excedía a esta publicación, mostrar también los análisis económicos realizados, que pueden contribuir en demostrar que se pueden reducir las pérdidas mejorardo la cosecha, el transporte, los envases y el manipuleo de la mercadería. Disminuyendo las pérdidas, se hace más sustentable la producción y se puede pensar en aplicar tecnologías poscosecha.
REFERENCIAS BIBLIOGRÁFICAS
Aldaz E, Romero A (1986) Evaluación de pérdidas poscosecha de tomate y aguacate e inventario de embalajes utilizados. Tesis de grado académico (Ing. Alim.) Universidad Técnica de Ambato, Ecuador. 119p.
Bond M, Meacham T, Bhunnoo R, Benton TG (2013) Food waste within global food systems. A Global Food Security Report. www.foodsecurity.ac.uk. Accesso Junio 2017.
Castro L, Cortez Barbosa L, Jorge J (2001) Influência da embalagem no desenvolvimento de injúrias mecánicas em tomates. Ciência Tecnologia Alimentos, 21:26-33.
FAO (2014) Pérdidas y desperdicios de alimentos en América Latina y el Caribe. http://www.fao.org/3/a-i3942s.pdf. Accesso Junio 2017.
Ferratto J et al. (2009) Efecto de los procesos de cosecha, empaque y comercialización en las pérdidas y daños poscosecha de tomate. Horticultura Argentina, 28(66):26-31.
Ferratto J, Firpo I, Rotondo R, Mondino MC (2010) Incidencia de una nueva tecnología de cosecha en la calidad poscosecha de frutos de tomate con distinto grado de madurez. Horticultura Argentina, 29(70):12-17.
Ferratto J et al. (2012) Pérdidas poscosecha de hortalizas en negocios minoristas, con distintos sistemas de manejo, en Rosario, Santa Fe Argentina. Horticultura Argentina, 31(75): 21-27.
Firpo I et al. (2007) Procesos, daños y pérdidas poscosecha del alcaucil en el Cinturón Hortícola de Rosario. Ciencias Agronómicas, 7(12):15-23.
Firpo I et al. (2010) Incidencia del embalado a granel en los daños y pérdidas poscosecha de frutos de tomate con distinta madurez, Ciencias Agronómicas, 16:35-38.
304 desarrollo sostenible
Firpo I et al. (2012) Incidencia del ambiente y la revitalización en las pérdidas poscosecha de hortalizas de hoja, fruto y raíz, Ciencias Agronómicas, 20:713.
Firpo I et al. (2015) Características de la comercialización minorista de hortalizas para distintos sectores sociales de Rosario (Santa Fe), Horticultura Argentina, 34(83):5-13.
García Winder M et al. (2009) Cadenas agroalimentarias: un instrumento para fortalecer la institucionalidad del sector agrícola y rural. Comuniica (IICA), 5(2):26-38.
Godfray H et al. (2010) Food security: the challenge of feeding 9 billion people, Science, 327:812–818.
Grasso R et al. (2013) Censo 2012 del Cinturón Hotícola de Rosario. Ajuste del Diagnóstico Agronómico de necesidades y estrategias de intervención del Proyecto Hortícola de Rosario 2013/2018. INTA Publicaciones Miscelánea, 50. 31p.
Grasso R et al. (2014) Evaluación de pérdidas poscosecha de hortalizas en dos formas de comercialización minorista, para el periodo invernal y estival en Rosario, Santa Fe, Argentina. www.horticulturaar.com.ar. Acceso Junio 2017.
Grasso R et al. (2018) Efecto de distintos sistemas de producción y formas de sujeción sobre las pérdidas poscosecha en Acelga (Beta vulgaris var. cicla L.). FAVE, Sección Ciencias Agrarias, 17(1):21-33.
INTA-RIA (2013) Revista de Investigaciones Agropecuarias, 39(3). http://ria. inta.gob.ar/sites/default/files/numeros/ria3932013.pdf. Acceso abril 2019.
Handenburg R, Watada A, Yi Wang C (1988) Almacenamiento comercial de frutas, legumbres y existencias de floristerías y viveros, 149p.
Kader A (2007) Tecnología poscosecha de cultivos hortofrutícolas. Serie de Horticultura Poscosecha, 3ed, Universidad de California, 24, 571p.
Lipinski B et al. (2013) Reducing food loss and waste. Installment 2 of “Creating a Sustainable Food Future”. Washington, DC, world Resources Institute. http://www.worldresourcesreport.org, 40p. Acceso abril 2019.
Liu G (2014) Food losses and food waste in China: a first estimate. OECD Food, Agriculture and Fisheries Papers, nº66. OECD Publishing, Paris, 29p.
Llach J, Harriague M, O´Connor E (2004) La generación de empleo en las cadenas agroindustriales, Fundación Producir Conservando. Argentina, 20p.
Mondino M et al. (2007) Pérdidas poscosecha de lechuga, en la región de Rosario, Argentina. Horticultura Argentina, 26(60):17-24.
Namesny Vallespir A (1993) Post Recolección de Hortalizas. Vol. I Hortaliza de hoja, tallo y flor. Ediciones de Horticultura, S.L., 330p.
Nakama M, Lozano Fernandez J (2008) Boletín electrónico de tomate Nº 13. http://www.mercadocentral.com.ar. Acceso abril 2019.
Nunes M, Edmond J, Rauth M, Dea S, Chau K (2009) Enviromental condiction sencountred during typical consumer retail display afecct fruit and vegetable quality and waste. Postharvest Biology Technology, 51:232-241.
Ortiz Mackinson M et al. (2014) Evaluación de alternativas de manejo de poscosecha en hortalizas de hoja sobre las pérdidas a nivel minorista. FAVE, Sección Ciencias Agrarias 13 (1):41-54.
305 Pérdidas de alimentos
Ortiz Mackinson M et al. (2017) Efecto de distintos sistemas de producción y formas de sujeción sobre las pérdidas poscosecha de rúcula. Horticultura Argentina, 36(91):110-121.
Parfitt J, Barthel M, Macnaughton S (2010) Food waste within food supply chains: quantification and potential for change to 2050. Philosophical Transactions of the Royal Society B, 365:3065–3081.
Paull R (1999) Effect of temperature and relative humidity on fresh commodity quolity. Department of Horticulture, College of Tropical Agriculture and Human Resources, University of Hawaii, Postharvest Biology and Technology, 15:263-277.
Rotondo R, Firpo I, Ferratto J, Ortiz Mackinson M (2010) Efecto de algunas técnicas de clasificación de frutos de tomate sobre la calidad poscosecha, FAVE Ciencias Agrarias, 9(1-2):1-6.
Rotondo R, Ferratto J, Firpo I, Mondino C, Cosolito P (2013) Efecto del ambiente de almacenamiento, la hidratación y el material de sujeción de los manojos, en las pérdidas poscosecha de hortalizas de hojas, a nivel minorista, Horticultura Argentina, 32(77):5-13.
Rotondo R et al. (2018) Influencia del sistema de producción y forma de sujeción en el rendimiento y las pérdidas poscosecha de espinaca (Spinacia oleracea L.), Ciencias Agronómicas, 32(18):26-33.
UNEP (2014) Prevention and Reduction of Food and Drink Waste in Businesses and Households Guidance for Governments, Local Authorities, Businesses and Other Organisations, Version 1.0. http://www.fao.org/fileadmin/user_ upload/save-food/PDF/Guidance-content.pdf. Acceso abril 2019.
Vilela N, Luengo R (2002) Viabilidade técnica e econômica da Caixa Embrapa para Comercialização de tomate para consumo in natura, Horticultura Brasileira, Brasília, 20(2):222-227.
Viteri M, González V, Carrozzi L (2000) Calidad visual en tomate, lechuga y pimiento en el nivel minorista de la ciudad de Mar del Plata. Efecto del manejo poscosecha. Balcarce. http://www.inta.gov.ar/balcarce/info/documentos/econo/mercado/hortal.htm. Acceso abril 2009.
Wheeler T, von Braun J (2013) Climate change impacts on global food security, Science, 341: 508-513.
Wills R, Glasson B, Graham D, Joyce D (1999) Introducción a La fisiología y manipulación poscosecha de frutas, hortalizas y plantas ornamentales. 2nd ed. Editorial Acribia S.A. Zaragoza, España, 240p.
306 desarrollo sostenible
18
ALTERNATIVAS DE MERCADO PARA O DESENVOLVIMENTO DA AGRICULTURA FAMILIAR
Oscar José Rover1 & Pablo Saravia Ramos2
1 Universidade Federal de Santa Catarina (UFSC), Centro de Ciências Agrárias, Programa de Pósgraduação em Agroecossistemas, Rod. Admar Gonzaga, 1346, 88034-001, Florianópolis-SC, Brasil. E-mail: oscar.rover@ufsc.br
2 Universidad de Playa Ancha (UPLA), Observatorio de Participación Social y Territorio, Facultad de Ciencias Sociales, Av. Playa Ancha 850, Playa Ancha, Chile. E-mail: pablo.saravia@upla.cl
INTRODUÇÃO
Os mercados agroalimentares são complexos e repletos de especificidades, as quais passam por elementos territoriais, de sazonalidade produtiva, de grupos sociais envolvidos com os processos produtivos, de tecnologias que mobilizam para ativar tais processos, assim como, de fatores externos que os interpelam.
A complexidade dos mercados agroalimentares é também resultado de sua crescente globalização e diversificação de atores socioeconômicos envolvidos, o que vem se ampliando nas últimas décadas a partir do processo de modernização agropecuária, o qual vem gerando dinâmicas de mercantilização em diferentes territórios rurais e contextos de produção agrícola. De sistemas produtivos que se ativavam sob forte articulação com as condições ecossistêmicas e dos grupos humanos disponíveis, a modernização crescentemente vem configurando sistemas produtivos com forte dependência de meios técnicos (tração motomecanizada, adubos de alta solubilidade, pesticidas, etc) e de fatores externos (crédito rural, políticas de preços, mercados, etc).
Este capítulo, visa analisar elementos da relação entre os sistemas produtivos agropecuários e os mercados, estes entendidos como um fator externo que tem forte capacidade de orientar a organização de diferentes sistemas de produção. Contudo, os mercados agroalimentares são aqui considerados na sua dupla face, de um lado, como meros espaços organizativos de troca de bens, serviços e recursos, e de outro, como espaços onde se constroem alternativas à visão dominante de que os alimentos seriam uma simples mercadoria. Partimos do pressuposto de que os alimentos são centrais para a vida humana e a organização social, a partir do que problematizamos a sua compreensão como simples mercadorias transacionadas em mercados abertos.
O capítulo está organizado nas seguintes partes: inicialmente apresentamos elementos básicos sobre a organização dos mercados alimentares, para Stadnik MJ, Velho AC, Zorrilla SE (eds.) Desenvolvimento Sustentável na Produção Agroalimentar
307
auxiliar quem não tem domínio aprofundado sobre o tema a avançar em sua análise. Ao final deste mesmo item demonstramos como vem se dando uma “virada para a qualidade” nestes mercados, como isto tem valorizado alimentos orgânicos/agroecológicos e como este perfil de demanda tem estimulado a criação de cadeias curtas de abastecimento de alimentos. Ao final, antes de apresentar algumas conclusões, ponderamos sobre os espaços de construção social de mercados para agricultores familiares (campesinos) e seus territórios, os quais se têm aberto em diferentes contextos sociais.
1. ORGANIZAÇÃO DOS PROCESSOS DE COMERCIALIZAÇÃO DE ALIMENTOS
Há uma diversidade de atores que atuam numa cadeia que envolve a produção, distribuição e abastecimento de alimentos. Os agricultores estão no início desta cadeia (Fig. 1), em sua maioria inseridos em territórios rurais, com baixa densidade demográfica, e estando dispersos, são numerosos e muitas vezes pouco organizados. Eles representam o elo da produção, o mais importante porque sem eles não haveria os demais, porém também um dos mais frágeis.

FO r NECEDO r ES DE INS u MOS


ATACADISTAS









Figura 1. Esquema geral dos atores dos sistemas de comercialização de alimentos.
Seus produtos podem integrar cadeias ou circuitos mais longos de comercialização, os quais podem ter vários intermediários, ser produzidos distantes dos consumidores e revelar uma assimetria informativa maior ao longo da cadeia de comercialização. Por outro lado, podem integrar circuitos mais curtos de comercialização, com menos intermediários, sendo produzidos geograficamente mais próximos dos consumidores, gerando menos assimetria informativa, reduzindo o impacto ao meio ambiente (pegada ecológica) e, em ocasiões, propiciando espaços educativos de formação e transferência de in-
308 desenvolvimento sustentável
DISTRIBUIDORES
VAREjISTAS VAREjISTAS CONS u MIDO r ES
AGRICULTORES
formação. Este último permitiria gerar um maior reconhecimento dos atores envolvidos sobre os processos produtivos e sua distribuição. Os circuitos mais longos são normalmente identificados como aqueles mais globalizados, fortemente concentrados e onde as grandes superfícies de varejo (supermercados) cumprem um papel relevante. Neles participam vários intermediários entre os produtores e os consumidores, enquanto que os circuitos curtos de comercialização podem ir de uma situação de venda direta, sem intermediários, até casos em que haja um intermediário (Fig. 2).




Situação A
Situação B









AGRICULTOR







Figura 2. Representação de circuitos longos e curtos de comercialização/abastecimento agroalimentar, considerando o número de intermediários.
Os diferentes atores socioeconômicos que operam em uma cadeia de comercialização/abastecimento de alimentos realizam vários serviços em torno da comercialização (Fig. 1): a reunião dos produtos que estão dispersos nas diferentes unidades produtivas e sua distribuição a pontos de venda no varejo são os principais serviços, especialmente quando se trata da comercialização de produtos in natura. Entretanto, vários outros serviços podem ser operados, como o processamento, o armazenamento, o transporte, a venda, sendo que todos eles geram custos e valor agregado aos produtos. Cada intermediário que se insere em uma cadeia de abastecimento cumpre algum papel na mesma, sem o qual ele não existiria. Entretanto, os mercados e as cadeias de abastecimento são campos sociais abertos à inovação e os papéis dos diferentes atores são ordinariamente revistos, podendo ser transitória sua importância e manutenção em dada cadeia. Um intermediário pode desempenhar desde uma venda até funções mais imprescindíveis, como armazenamento, transporte, processamento. Neste sentido, ele pode desempenhar papéis pouco relevantes aos interesses de agricultores e consumidores, ou pode ser o que em alguns contextos é denominado “intermediário
309 Produtos da agricultura familiar
AGRICULTOR CONSuMIDOr INTERMEDIÁRIO1 INTERMEDIÁRIO2 INTERMEDIÁRIO3 INTERMEDIÁRIO4
CADEIA LONGA DE ABASTECIMENTO AGROALIMENTAR
AGRICULTOR CONSuMIDOr INTERMEDIÁRIO1
CADEIA CURTA DE ABASTECIMENTO AGROALIMENTAR
INTERMEDIÁRIO
consciente”, uma vez que possuem uma sensibilidade ao trabalho do pequeno produtor e da agricultura familiar. Este tipo de intermediário pode ser encontrado, por exemplo, no caso das plataformas digitais de compra de alimentos na internet (Saravia 2019).
O conjunto de valores agregados aos bens/serviços, em função de serviços adicionados, gera um valor final que é pago por cada consumidor no momento da compra do alimento. Portanto, os circuitos comerciais que exijam menos serviços, menos intermediários e menos distâncias a percorrer, de maneira geral tendem a ter menos custos embutidos. Verificamos que os alimentos vêm sendo tratados como se fossem uma mercadoria como outra qualquer na dinâmica dos mercados agroalimentares globalizados. Eles se transformam em um bem transacionável em um mercado mundial no qual a especulação financeira e a concentração econômica determinam as condições dos fluxos, os preços e as disponibilidades de alimentos. No entanto, neste capítulo se tem como pressuposto que eles não são uma simples mercadoria, que eles são centrais para a vida e a saúde humana, para o conjunto da sociedade, e que suas formas de produção e distribuição produzem reflexos nas formas de organização social, na saúde humana e no ambiente natural. Suas formas de produção não produzem reflexos apenas sobre os diferentes ambientes naturais, como também dependem dele para se manterem estáveis e serem resilientes à crescente ocorrência de eventos climáticos extremos, como secas, inundações, vendavais, etc.
Compreender que os alimentos não são uma simples mercadoria nos leva a um tema que é muito destacado por um movimento social internacional, o Movimento Slow Food, qual seja, a “centralidade do alimento”. Isto remete à noção de segurança e soberania alimentar e nutricional, que se refere a um conjunto de garantias para que os alimentos estejam disponíveis em quantidade, qualidade e adequação à cultura alimentar de cada sociedade ou grupo social1 . Contudo, apesar de lançarmos outro olhar sobre os alimentos, destacando que eles não são uma mercadoria qualquer, é necessário também compreender que eles são transacionados nos mercados como mercadorias e, como tal, seguem pressupostos e regras que organizam os mercados em geral. Assim, este capítulo transita entre dois raciocínios complementares e contraditórios: por um lado, a centralidade dos alimentos e sua condição de não ser uma simples mercadoria, por outro, sua condição objetiva de transação nos mercados, a qual exige refletir como se organiza atualmente a maioria dos mercados agroalimentares (o que se tornou o convencional) e como são as formas que se propõem alternativas àquelas que são dominantes. Como os alimentos se referem a mercadorias que respondem por uma das necessidades mais básicas do ser humano, garantir seu acesso é um
1Não aprofundaremos este e outros temas de fundo que serão discutidos neste trabalho, pois aprofundar cada um exigiria um capítulo próprio Aqui apenas procuramos manifestar a relação entre a comercialização e os principais temas e noções relacionados às problemáticas dos sistemas agroalimentares mundo afora
310 desenvolvimento sustentável
tema central, principalmente se consideramos que a fome segue sendo um dos maiores problemas à escala mundial2. Para tanto, nos processos de comercialização se procura conduzi-los dos produtores aos consumidores pelo preço mais baixo possível, o que remete à necessidade de atenção aos componentes que ampliam os custos dos produtos. A redução dos custos nas cadeias convencionais de produção e abastecimento é promovida, na maioria das vezes, por uma forte pressão sobre os preços pagos aos produtores. Como o preço por unidade tende a ser baixo, se gera dentro dos próprios sistemas agrários e produtivos pressão por crescentes produtividades e ganhos de escala. Esta lógica, preponderante nos sistemas agroalimentares convencionais, gera um forte processo de seletividade e exclusão dos agricultores menores.
Em contra tendência às lógicas dominantes surgiram diversos movimentos que se organizaram inicialmente na Europa, com a agricultura biodinâmica na década de 1920, que ao longo de um século de sua construção mundo afora propõem outras abordagens de produção, de comercialização e de consumo alimentar. Tratam-se de inúmeros movimentos sociais e econômicos que vêm sendo abarcados nas noções de Redes Agroalimentares Alternativas (RAA) e mais recentemente Redes de Cidadania Agroalimentar (RCA) – (Lamine et al. 2012, Renting et al. 2003, Renting e Marsden 2017). Tais abordagens de produção e abastecimento agroalimentar avançaram com muita rapidez nas últimas três décadas, devido à crescente desconfiança dos consumidores em relação aos alimentos, assim como ao crescimento da percepção quanto à existência de uma crise ambiental em nível global. Tal desconfiança é motivada por escândalos alimentares, pelo advento dos transgênicos e pelo crescente uso de agrotóxicos, o que vem gerando uma crescente percepção de muitos consumidores quanto aos riscos que envolvem a aquisição e consumo de alimentos convencionais. Essas situações promovem nos consumidores a busca por alimentos orgânicos, agroecológicos, funcionais, coloniais e artesanais. Assim, revalorizando tradições, variedades locais perdidas, processos produtivos localizados, que garantam alimentos de qualidade superior e um processo crescente de recuperação do gosto/sabor dos alimentos, assim como de algum controle sobre as dinâmicas de abastecimento.
As transformações acima descritas vêm na esteira de um processo mais amplo de ampliação dos mercados para bens e serviços ambientais, voltados à redução de pegada ecológica e reintegração humano-natureza. Especificamente no campo agroalimentar vem se produzindo uma virada para a qualidade (Goodman 2003), na qual produtos derivados de modos de produção agroecológico e orgânico são o principal apelo dos consumidores (Kneafsey 2013).
Entretanto, um dos problemas dos alimentos agroecológicos e orgânicos é seu preço final e a (im)possibilidade de acesso a grande número de consumidores. Este problema não deriva, necessariamente, de maiores custos de produção, visto que os custos vão depender muito de qual é o produto tran-
2Segundo FAO, FIDA, UNICEF, PMA e OMS (2018) eram 821 milhões de famintos no mundo em 2017.
311 Produtos da agricultura familiar
sacionado e de como se organiza sua cadeia de abastecimento, mesmo que sua eficiência produtiva em bases agroecológicas/orgânicas deva ser considerada cuidadosamente3. Sabe-se, contudo, que quanto menor for a extensão da cadeia de abastecimento, menores poderão ser as margens de agregação de valor que ficarão com intermediários, resultando em preços finais mais acessíveis. Não seria por outro motivo que o estudo sobre cadeias curtas de comercialização realizado na Europa identificou que a busca de acesso a alimentos orgânicos foi o principal motivador para os consumidores se integrarem a este tipo de circuito comercial (Kneafsey 2013). Das reflexões até aqui aportadas para entender os mercados convencionais e alternativos de alimentos, podemos sintetizar que enquanto ocorre, em nível global, uma forte concentração de atores na distribuição alimentar, materializada em grandes centros de estocagem e grandes superfícies de supermercados, ocorrem outros dois movimentos paralelos: há um aumento crescente da demanda e organização de consumidores para acessar alimentos de qualidade superior; os mercados agroalimentares têm se diversificado e segmentado, abrindo espaço para diversas possibilidades de inserção para os agricultores, para suas organizações, assim como para novas formas de articulação entre produtores e consumidores. Disto resulta que internacionalmente coexistem diferentes e contraditórios sistemas de produção e abastecimento, que ao mesmo tempo em que se conflituam, geram hibridizações de situações e possibilidades de organização produtiva, social e comercial. Na sequência, aprofundaremos às possibilidades inovadoras que vêm se organizando no campo das RAA e RCA, com ênfase na abordagem dos circuitos curtos de comercialização (CCC) (Darolt 2013, Lamine et al. 2012).
2. CONSTRUÇÃO SOCIAL DE MERCADOS PARA AGRICULTORES FAMILIARES E SEUS TERRITÓRIOS
Da reflexão até aqui, deduz-se que há muito espaço para novas construções sociais de mercados agroalimentares e que os consumidores, como geradores de demanda, devem ser considerados com maior relevância. Nas transições recentes dos mercados se tem seguido uma tendência de orientar a produção pela demanda, diferentemente de uma forma tradicionalmente adotada pelos agricultores, que era primeiro ter o produto para depois identificar para quem vender. Isto remete à necessidade de outra atitude dos produtores e de suas organizações, assim como de instituições de pesquisa e apoio. Desta forma, se faz necessário refletir sobre os principais elementos para qualificar processos de comercialização que, orientados pela demanda,
3Ao realizar uma meta-análise de estudos que, mundo afora, compararam rendimentos entre sistemas de produção convencional e orgânicos, Seufert et al. (2012) concluíram que sob certas condições (boas práticas de gestão, determinados tipos de culturas e condições de desenvolvimento) os sistemas orgânicos podem obter produtividades semelhantes aos convencionais.
312 desenvolvimento sustentável
beneficiem combinadamente os agricultores familiares4 e a sustentabilidade dos territórios rurais onde eles estão inseridos. Para tanto é necessário compreender que existem algumas questões centrais a considerar, relativas à demanda dos alimentos:
• Há espaço para antecipação e alteração de demanda, e que para isto se deve considerar os desejos e expectativas dos consumidores, para o momento e o futuro, considerando o que eles esperam em relação ao tempo, lugar, forma, preço e qualidade dos produtos;
• Que faltam informações e articulação entre produtores e consumidores, e que estes dois segmentos podem ficar bastante vulneráveis em processos comerciais operados por intermediários que promovem a relação entre eles.
Na perspectiva de qualificar uma construção social de mercados que valorizem os agricultores e seus territórios, e os aproximem dos consumidores, há que se considerar também um elemento central relacionado à oferta dos alimentos: a necessidade de ganhos de escala para melhor se inserir nos mercados, otimizando logísticas comerciais. Quando se trata de agricultores familiares, a obtenção destes ganhos de escala se dá, geralmente, através de formas de cooperação. Neste sentido, a construção de formas de cooperação entre os produtores e a formação de redes entre suas organizações é uma debilidade central da dinâmica de oferta dos alimentos. Aqueles que não avançam nesta questão limitam seu potencial de enfrentar os processos exigidos pelos mercados, que têm como tendência geral a transformação dos alimentos em simples mercadorias.
Entretanto, há diversas experiências de construção social e coletiva de mercados, de articulação entre agricultores, entre suas organizações, assim como destas com consumidores e suas organizações. Há um grande espaço para novas redes e construção de mercados que reduzam as distâncias entre produtores e consumidores, gerando novas cadeias de abastecimento de alimentos (Darolt 2013, Marsden et al. 2000).
Uma cadeia comercial pode ser considerada curta quando a redução de distâncias entre produtores e consumidores é compreendida em dois sentidos: relacional e espacial, sendo que a relacional implicaria em reduzir intermediários entre eles, enquanto a espacial diz respeito a reduzir as distâncias, ativar novas transações locais, incentivar o consumo de produtos do e no seu território5 . Os CCC geram um importante conjunto de impactos ao aproximarem quem produz de quem consome, podendo reduzir custos de logística;
4Vale destacar que a agricultura familiar e camponesa, mundo afora, representa a ampla maioria dos estabelecimentos agropecuários, assim como é responsável por grande parte da diversidade produtiva de alimentos, mesmo que sejam minoria em quantidade de terras disponíveis para suas atividades. 5Outros autores (Marsden et al. 2000) indicam que um circuito comercial espacialmente estendido também pode ser considerado curto. Compreendemos que esta abordagem não dá o necessário valor às questões territoriais, locais e de pegada ecológica, e desta forma preferimos definir como curtas aquelas cadeias que reduzem distâncias nas duas dimensões: relacional e espacial.
313 Produtos da agricultura familiar
permitir qualificar a produção através de sinais da demanda; e permitir aos consumidores reconhecerem elementos de sazonalidade, intempéries e outras restrições próprias da produção. Processos como este têm potencial de partilhar entre agricultores e consumidores as responsabilidades pelo conjunto produção-abastecimento, gerando compromissos compartilhados. Entretanto, este tipo de movimento exigiria dois deslocamentos: dos agricultores e suas organizações que avançassem nas etapas de reunião e distribuição dos produtos, para fazê-los chegar com custos e qualidade adequados aos consumidores; dos consumidores que tivessem um maior grau de participação nos mercados, exigindo sua organização e saída da condição de meros clientes. Dessa maneira, os desafios são de ordem produtivo-organizacional, assim como político-educativos, já que se requer uma transformação na valorização cultural do trabalho dos agricultores e na construção de consumidores mais analíticos em relação ao sistema agroalimentar convencional. Muitas são as modalidades de cadeias curtas de abastecimento. Um estudo na região de Valparaíso, Chile, identificou três modalidades que visam diminuir a lacuna entre os produtores e consumidores. A primeira são as denominadas plataformas digitais (“Canasta Orgánica”; “Zaqui”; “NewenMapu” y “Organicolibrí”), que funcionam como um espaço virtual de compra de produtos alimentícios, no qual o consumidor escolhe, a partir de uma lista, os produtos que necessita e o gestor da página entrega em seu domicílio. A segunda são as feiras públicas (“Eco Viva”; “Bioferia”; “Ecoferia Integral”; “Feria Orgánica” e os “Mercados Campesinos”), que por sua vez têm diferenças em suas trajetórias, bem como em suas relações com o Estado, já que algumas delas (ex.: os Mercados Campesinos) nascem a partir de uma iniciativa do poder público, enquanto outras são resultados de dinâmicas de autogestão. Elas estão em espaços públicos e são de livre acesso para os consumidores. Por fim, o terceiro canal presente na região são as cooperativas de consumidores (“La Porteña; “Orígenes” y “Alma”), que apresentam muitas diferenças entre si, devido às distintas origens históricas, estágios de desenvolvimento e posturas políticas em relação aos seus objetivos (Saravia 2019). As modalidades identificadas nesta região chilena não diferem muito de outros contextos socioeconômicos, contudo, além delas, poderíamos citar a venda direta nas propriedades, venda a restaurantes, dentre outras modalidades (ou circuitos) curtas6. As diversas modalidades de cadeias curtas de abastecimento se enquadram na noção de RAA, pois buscam outras possibilidades de organização e funcionamento relativamente às cadeias convencionais. Entretanto, muitas delas se organizam sem uma efetiva articulação entre si, com outras organizações de produtores e consumidores, ou com organizações e instituições de apoio. Isto traz o risco de um isolamento de cada iniciativa, limitando seu potencial de se inserir nas dinâmicas de concorrência, muitas vezes agressivas, dos mercados agroalimentares.
6Para aprofundar este tema recomendamos Darolt (2013)e Lamine et al. (2012).
314 desenvolvimento sustentável
Compreender que processos econômicos, nos quais se inserem as dinâmicas de comercialização de alimentos, estão imersos em dinâmicas sociais diversas, derivadas de elementos naturais, territoriais, culturais, dentre outras, nos permite falar em economias no plural, em processos econômicos complexos, muitas vezes contextualizados territorialmente. Nesta complexidade é importante destacar que os alimentos têm forte dependência das condições edafo-hidro-climáticas de cada território e das escolhas alimentares das diferentes culturas humanas. Isto é, a comida não é somente a materialização de um processo produtivo necessário para a sobrevivência humana, mas é também uma oportunidade de construir novos referentes territoriais a partir de relações heterogêneas, através das quais os atores dão forma a um território em particular. Em diferentes territórios locais/regionais, conforme as capacidades organizativas de diferentes atores sociais, dentre os quais estão os agricultores, os consumidores e suas organizações, processos que considerem a centralidade do alimento permitiriam recuperar, construir e imaginar territórios organizados em dinâmicas sociais e políticas mais equilibradas que aquelas propostas pelo sistema agroalimentar convencional.
A crescente demanda dos consumidores por acessar alimentos menos processados, industrializados, com processos produtivos mais ecológicos e com alguma carga de tipicidade, tem produzido uma dinâmica de revalorização da proximidade, assim como a revalorização de produtos artesanais, crioulos, típicos, regionais, enfim, com alguma carga de identidade territorial. Um processo como este permitiria gerar maior diversificação dos sistemas produtivos e das cadeias de abastecimento, o que vem na esteira de um processo mais amplo de transformação no conjunto dos mercados: as diferentes formas de segmentação dos mercados, que ampliam possibilidades para criação de dinâmicas organizativas que articulem produtores, consumidores e suas organizações, visando atender uma demanda crescentemente complexa e diversificada por produtos de maior qualidade.
“As dinâmicas produtivas de alimentos podem ser mais intensamente enraizadas em seus territórios. A partir das novas demandas dos consumidores se podem também ampliar as dinâmicas de distribuição e consumo territorializados”.
A busca de muitos consumidores por maior conhecimento sobre os processos produtivos e sobre os atores sociais envolvidos nas cadeias alimentares tem contribuído para construir mercados mais relacionais, territorializados, com identidades específicas. Entretanto, quando os agricultores e suas organizações avançam na construção deste tipo de mercado, muitas vezes negligenciam cuidados necessários às dinâmicas de distribuição e abastecimento, isto é, a maior atenção muitas vezes dada aos processos produtivos negligencia os processos comerciais, que muitas vezes são os responsáveis por viabilizar ou não os resultados desejados.
315 Produtos da agricultura familiar
No contexto da “virada para a qualidade”, para além da produção diferenciada dos alimentos, assim como de suas dinâmicas de distribuição e abastecimento, há que se considerar a gestão estratégica do agroalimentar no território. Muitos atores com interesses que se interseccionam desenvolvem iniciativas pontuais e individualizadas, sem efetivos diálogos que poderiam potencializar as diferentes iniciativas. Um diálogo entre produtores, consumidores, suas organizações, organizações de apoio e instituições públicas, valorizando as culturas alimentares (produtivas e de consumo) e a agrobiodiversidade local, assim como ampliando o acesso à alimentação de qualidade superior, poderia produzir uma gestão estratégica do agroalimentar no território local.
CONSIDERAÇõES FINAIS
Os modos convencionais de produção, distribuição e consumo de alimentos tem consequências em praticamente todas as dimensões da vida das pessoas, um multi-efeito que adverte sobre a relevância de propiciar mudanças econômicas, políticas e culturais que devolvam aos territórios parte importante do controle sobre as dinâmicas relacionadas à alimentação. Isto permitiria avançar para maiores níveis de soberania alimentar nos territórios, o que exigiria potencializar a articulação entre as alternativas que existem nesta matéria.
Muitos dos coletivos que potencializam alternativas alimentares estão muitas vezes trabalhando de maneira isolada em um mesmo território, sem maior articulação com experiências similares. A sinergia e os impactos positivos de um trabalho em rede potencializariam cada experiência em si mesma, além de contribuir para sua divulgação e reflexão na cena pública, problematizando sobre a urgência de modificar as formas com as quais nos relacionamos com o sistema agroalimentar convencional. Uma maior difusão de redes territorializadas de cidadania agroalimentar problematizaria o caráter global do sistema agroalimentar convencional, em seus efeitos sobre o meio ambiente, sobre o manejo dos recursos e sobre a construção social dos habitats rurais e urbanos. Neste contexto, deslocar a problemática dos alimentos de qualidade superior de uma condição elitizada, despolitizada e individual, para outra de acesso ampliado e construído coletivamente, permitiria que os arranjos de produção, abastecimento e consumo auxiliassem na transição para modos de produção efetivamente sustentáveis.
Reduzir as distâncias (relacionais e espaciais) entre a produção e o consumo de alimentos é um fator chave nesta construção, já que permite reduzir a importância estratégica da figura do intermediário, assim como a pegada ecológica. Isto significaria aproximar o mundo produtivo (em sua maioria localizado nos espaços rurais) dos consumidores (presentes majoritariamente nas cidades), gerando um diálogo sobre as necessidades de cada um, as tendências, os conflitos e as oportunidades que se colocam. A construção deste
316 desenvolvimento sustentável
diálogo permitiria um reconhecimento mais detalhado e complexo sobre o outro e potencializaria as oportunidades produtivas e educativas, já que permitiria identificar e priorizar as iniciativas que são cruciais para um projeto de interesse comum para seu futuro. Conjuntamente, é necessário compreender que a construção deste horizonte transformador não pode ser feita isolado das políticas e instituições públicas, das universidades, das organizações não governamentais e de outros espaços coletivos de trabalho.
É urgente estabelecer canais eficientes e eficazes de diálogo e trabalho colaborativo com esses atores, em uma dinâmica organizativa que respeite as particularidades (potenciais e limitações) de cada um. Uma tarefa como esta não pode perder a atenção para a necessária autonomia dos atores socioeconômicos locais, especialmente quanto às tentativas de instrumentalização por parte do Estado ou as formas extrativas de saber promovida por muitos trabalhos acadêmicos.
A construção de alternativas alimentares, buscando modificar os modos de produção, distribuição e consumo convencional, tem se mostrado como potente promotora de inclusão socioeconômica e cuidado ambiental. A agricultura familiar e camponesa tem nestas alternativas, em um contexto de crescente demanda por produtos de qualidade superior, uma oportunidade de se inserir, gerando trabalho, renda e novos espaços comerciais para seus produtos. Avançar neste tipo de processo permitiria construir e imaginar territórios ativos, que discutem, propõem e defendem os cada vez mais escassos equilíbrios ecológicos existentes.
REFERêNCIAS BIBLIOGRÁFICAS
Darolt MR (2013) Circuitos curtos de comercialização de alimentos ecológicos: reconectando produtores e consumidores. In: Niederle PA et al., Agroecologia: práticas, mercados e políticas para uma nova agricultura. Curitiba, Kairós, pp. 139-170.
FAO, FIDA, UNICEF, PMA y OMS (2018) El estado de la seguridad alimentaria y la nutrición en el mundo. Fomentando la resiliencia climática en aras de la seguridad alimentaria y la nutrición. FAO, Roma, 219p. Goodman D (2003) The quality ‘turn’ and alternative food practices: reflections and agenda. Journal of Rural Studies, 1(19):1-7. doi: 10.1016/S07430167(02)00043-8
Kneafsey M et al. (2013) Short Food Supply Chains and Local Food Systems in the EU: A State of Play of their Socio-Economic Characteristics Publications Office of the European Union, Luxembourg, 128 p.
Lamine C, Darolt M, Branderburg A (2012) The Civic and Social Dimensions of Food Production and Distribution in Alternative Food Networks in France and Southern Brazil. The International Journal of Sociology of Agriculture and Food, 19(3): 383-401.
317 Produtos da agricultura familiar
Marsden T, Banks J, Bristow G (2000) Food Supply Chain Approaches: Exploring their Role in Rural Development Sociologia Ruralis, Sociologia ruralis, 40(4): 424-438.
Renting H, Marsden TK, Banks J (2003) Understanding alternative food networks: exploring the role of short food supply chains in rural development. Environment and Planning A, 35(3):393-411.
Renting H, Marsden TK (2017) Uma réplica ao artigo: Understanding alternative food networks: exploring the role of short food supply chains in rural development, In: Gazolla M, Schneider S, Cadeias curtas e redes agroalimentares alternativas: negócios e mercados da agricultura familiar, Edufrgr, Porto Alegre, pp 53-58.
Saravia P (2019) Canales Cortos de Comercialización en la región de Valparaíso, Chile Estado de la cuestión y proyecciones de futuro (no prelo).
Seufert V, Ramankutty N, Foley JA (2012) Comparing the yields of organic and conventional agriculture, Nature, 485(7397):229:232.
318 desenvolvimento sustentável